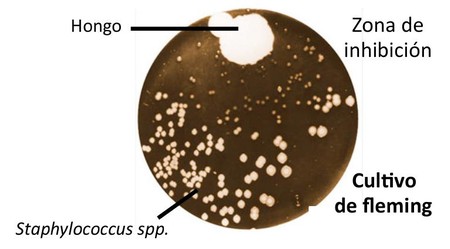

"Corría el año 2017 y…". Siempre me ha parecido una manera perfecta (a alguien se lo había escuchado antes) de comenzar a contar una historia. Pues sí, corría el año 2017, más concretamente el mes de Abril, en los días de Semana Santa y para no romper con una "tradición" que nos habíamos auto impuesto el año anterior, ahí estábamos los cuatro haciendo una parte del Camino de Santiago.
En uno de esos días, llegando a Burgos, a Pablo se le escapa el balón de balonmano, si incomprensiblemente lleva toda la semana cargando con el balón, empieza a rodar por una pequeña pendiente hasta que unos metros más abajo y tras una pequeña carrera lo vuelve a coger. Ya por la tarde en el albergue y tras una reparadora ducha y una no menos reparadora merienda me viene a la cabeza el rodar del balón. Le comento a Pablo que si se había fijado que el balón había empezado a correr camino abajo y tras un rato parecía que mantenía la velocidad y que ya no se aceleraba más, a lo que me responde, "si, si, pero podemos jugar un rato con la tablet o salir fuera a lanzarnos el balón" (con la tablet carga su hermano). Resignadamente, con el comentario entre dientes de "que poco científico que eres", respondo "claro que podéis jugar a lo que queráis, os lo habéis ganado". Días más tarde, de vuelta ya en Madrid, recuerdo aquella tarde y nace la idea de esto que estáis comenzando a leer.
Este libro surge como la recopilación de las respuestas de unos buenos amigos, en origen a la mayoría de ellos no los conocía pero ya los considero a todos buenos amigos, a mi solicitud de "Por favor, me gustaría que me ayudarais a animar/motivar a mis hijos a que sean científicos".
Este "guante" se lo lancé a multitud de científicos y tras el consejo de Ana Ulla "Quintín intenta que seamos muchas las científicas las que participemos en este libro así será un mayor aliciente y ejemplo para las chicas", pues intenté, y creo que conseguí, un buen número de grandes científicas, claro está los científicos que participan no les van a la zaga. Vaya desde aquí mi agradecimiento a todos los que han participado, todos de una manera altruista, por su ayuda, dedicación, entusiasmo y por hacer mi labor de coordinación fácil y llevadera. Por supuesto hago extensible este agradecimiento a todos los que no han podido participar, gracias por vuestro ánimo y buenos consejos.
Este libro va dirigido a jóvenes, o esa era la idea inicial, lectores de entre 14-18 años, pero tengo que confesar que tras su lectura creo que será del agrado de cualquier persona con un mínimo de curiosidad, sea cual sea su edad. Pienso que en esta colección de relatos, en su mayoría vivencias personales de sus autores, encontrareis un fiel reflejo de la comunidad científica actual. Entre los autores encontraréis desde estudiantes de grado o doctorado a Catedráticos, e incluso científicos ya jubilados (en la mayoría de los casos muy a su pesar) con una sabiduría y experiencia que una Sociedad que se quiera calificar como Avanzada no debe dejar de lado y mucho menos en el olvido. Aquí tenéis un buen elenco de "hombros sobre los que subiros" para lograr grandes cosas. Creo firmemente que acabareis la lectura de los capítulos mascullando la frase "Y yo quiero ser…".
Decir que no es un libro que requiera una lectura continuada. Todos los capítulos son independientes, se pueden leer sin orden, se puede ir saltando de un área de conocimiento a otra sin problemas. Mi recomendación es que empecéis leyendo los que creáis que más os van a gustar. Para después no dejar de leer los que según los títulos no parece que os llamen la atención o incluso aquellos que leyendo el título no sepáis muy bien a que se están refiriendo, estoy seguro que os sorprenderán y gustaran.
Aprovecho para poner "la venda antes de la herida", soy el único culpable en la confección del índice. Son miles las posibles combinaciones para elaborarlo pero está claro que hay que decidirse por una y seguro que no será del agrado de todos. Esta combinación se basa en la separación de los capítulos en dos grandes áreas (por explicarlo de alguna manera, una con un poco menos de "matemáticas" y la otra con algo más) y dentro de ellas el orden alfabético de los propios capítulos. Serán muchas las opiniones que cambiarían de área y/o de orden los capítulos pero tenía que decidirme por algo.
Termino estas líneas volviendo a agradecer a todos los que de una manera u otra han participado en la elaboración de este libro, desde Irene a Federico por citar dos nombres ya que la lista completa sería inacabable. Una más que ganada mención, lo que habéis tenido que aguantarme, a David, Pablo y Teresa gracias por vuestro apoyo y ayuda.
Y con la esperanza que todos encontréis con la lectura de este libro la inspiración y el ánimo para conseguir ser grandes científicos.
Madrid, febrero 2018
Un abrazo
Quintín
Vivimos tiempos de crisis global y de grandes retos planetarios, que requieren más que nunca ser capaces de generar y aplicar nuevos conocimientos. Por ello, una de las responsabilidades de la comunidad científica es transmitir a la ciudadanía la relevancia de la investigación científica, como frontera intelectual que nos permite abordar preguntas fundamentales sobre el universo y sobre la vida, y también por su incidencia en el desarrollo y bienestar de la sociedad, en aspectos como la salud, la alimentación, la energía o el medio ambiente.
Este mensaje es esencial para que la sociedad y los responsables políticos apuesten por la ciencia como uno de los motores fundamentales de futuro, y es especialmente necesario en nuestro país, donde la inversión sostenida en I+D está lejos de ser una prioridad, a diferencia de lo que sucede en otros países de vanguardia. Y es también muy importante que ese mensaje se dirija de forma específica y eficaz a los más jóvenes, de cuyo talento e impulso renovador depende el futuro de la investigación científica.
En este contexto se enmarca la excelente iniciativa del libro "CIENCIA, y yo quiero ser científico!!!", que cuenta con la colaboración de la asociación Apadrina la Ciencia y otras instituciones, y que quiere contribuir, a través de los testimonios de muchos investigadores e investigadoras de diversas disciplinas, a que estudiantes de secundaria y bachillerato conozcan de primera mano las preguntas a las que se enfrentan los científicos, su forma de vida, y también su motivación y su pasión por sus distintas especialidades.
El sistema educativo y la sociedad en su conjunto precisa fomentar el interés por la actividad investigadora y despertar vocaciones científicas, a través de unos contenidos educativos sólidos y atractivos que combinen la transmisión de información (creciente en volumen y complejidad) sobre las distintas materias con el entrenamiento de la curiosidad, la capacidad de indagar y el espíritu crítico, y de una divulgación rigurosa y cercana.
Queremos (y necesitamos) que los jóvenes quieran dedicarse a la actividad científica:
- para seguir preguntándonos, sin más guía que la curiosidad innata de la condición humana, cómo son los seres humanos, los seres vivos, la naturaleza, el cosmos, en el ámbito de la investigación básica, que es la fuente de todo conocimiento y de toda posible aplicación futura ("no se puede planificar lo inesperado", en palabras del Premio Nobel Aaron Klug).
- para, a través de la implementación de nuevos conocimientos y procedimientos, contribuir a evitar o aliviar el sufrimiento de las personas, mejorar su bienestar y actuar a tiempo ante procesos potencialmente irreversibles en nuestro medio ambiente, a los que nos enfrentamos por primera vez en nuestra historia. "No hay ningún desafío que se sitúe más allá de la capacidad creadora distintiva de la especie humana", afirmó el Presidente John F. Kennedy en 1963.
La ciencia y la comunidad científica deben tener un papel decisivo y protagonista en los cambios radicales que precisa nuestro mundo. Conocer la realidad… y actuar en consecuencia. Ciencia para facilitar la transición desde una economía basada en la especulación, la deslocalización productiva y la guerra a una economía basada en el conocimiento para un desarrollo global sostenible y humano, en que las cinco prioridades de las Naciones Unidas -alimentación, agua, salud, medio ambiente y educación- sean asequibles a todos para vivir dignamente, y fundada en un nuevo concepto de seguridad que no sólo tenga en cuenta los territorios y fronteras, sino a los seres humanos que los habitan.
Deseamos vivamente que este libro sirva para fomentar que estudiantes de bachillerato y secundaria se sientan atraídos por la actividad científica y se sumen a las nuevas generaciones de investigadores (en las que las mujeres científicas tendrán un protagonismo creciente), y que así aporten decididamente su imaginación, su perseverancia, altura de miras, capacidad creativa e inconformismo (valores todos ellos consustanciales a la actividad científica) para tomar el relevo e impulsar estos cambios.
Federico Mayor Zaragoza
Presidente de la Fundación Cultura de Paz
Ex director General de la UNESCO
Federico Mayor Menéndez
Catedrático de Bioquímica y Biología Molecular de la Universidad Autónoma de Madrid y Ex Presidente de la Sociedad Española de Bioquímica y Biología Molecular (SEBBM)
Alguien me dijo en una ocasión: "Mira esta figura y dime qué respuesta darías a la pregunta del recuadro azul".

"Muy fácil", contesté. "Aumentaría la superficie cultivada, o la mantendría pero regaría un mayor porcentaje, y así se podría cubrir la demanda de alimento, fibra y biodiesel de los 3.000 millones de personas más que seremos en 2050. Me contestó: "No. No podemos usar más recursos naturales, por lo que hay que satisfacer dicha demanda sin aumentar la superficie cultivada ni usar más agua para el riego."
Esto es un reto. Y ser agrónomo significa, precisamente, dar una respuesta satisfactoria a retos como este. Los agrónomos buscamos soluciones a problemas como el mostrado desde distintos frentes: obtención de variedades más productivas, mejoras en las técnicas de laboreo, fertilizaciones más racionales, técnicas más efectivas para la protección de cultivos... Mi especialidad es el uso del agua en la agricultura, por lo que os voy a contar qué hacemos los agrónomos que nos dedicamos al riego para contribuir a la solución de este reto.
Para no irnos demasiado atrás, hablaremos de lo que hemos hecho desde mediados del siglo pasado hasta ahora. En estos 70 últimos años se han dado tres grandes pasos para optimizar el uso del agua en agricultura, es decir, para obtener más producción con menos agua. El primero se originó tras la creación del estado de Israel, en torno a 1950. Los judíos que acudieron desde todos los rincones del globo al nuevo estado se encontraron con unas tierras desérticas de las que debían obtener alimentos para una población en continuo aumento. Su iniciativa coincidió con la producción a escala industrial de un nuevo material, el plástico. Ambos elementos dieron lugar a un rápido desarrollo del riego por goteo que, aunque había sido inventado por los alemanes en el S. XIX, no se popularizó hasta que se pudieron fabricar piezas de plástico, un material barato y resistente. Aquel avance del riego localizado se extendió rápidamente a las zonas áridas y semiáridas de todo el mundo, dando lugar a un gran ahorro en el agua usada en agricultura.
El segundo gran paso en la racionalización del uso del agua en agricultura consistió en el desarrollo de estrategias de riego deficitario. Por ellas se entiende una forma de regar basada en el conocimiento de la respuesta del cultivo al aporte de agua. Destaca, como ejemplo, el riego deficitario controlado (RDC), que consiste en regar con suficiente agua para suplir las necesidades hídricas del cultivo en los momentos en los que este es más sensible al estrés hídrico; en el resto de su ciclo de crecimiento se riega muy poco, o nada. Se consigue, así, ahorros significativos de agua con escasa reducción de la producción. En la siguiente figura se muestra el esquema de una estrategia de riego RDC para el olivar.

Esta es una de las muchas estrategias de riego deficitario que se desarrollaron en países áridos como Australia y España, a partir de la década de los 80 del pasado siglo. El tercer gran paso en la mejora de la eficiencia del uso del agua en agricultura comenzó a principios de este siglo, en países con un elevado nivel tecnológico en esta ciencia. Se trata de lo que se conoce como riego de precisión. No es una técnica, ni un método, sino toda una filosofía de riego. Consiste en la sabia elección del sistema de riego (por surcos, por aspersión, por goteo…), de la estrategia de riego (riego complementario, riego deficitario controlado, riego deficitario sostenido…) y del método para la programación del riego (a partir de medidas de humedad del suelo, de la demanda atmosférica, del grado de deshidratación de la planta...). Se trata de conseguir nuestro objetivo productivo con el menor consumo de agua y energía posibles. Del sistema de riego y de la estrategia de riego ya hemos hablado. En lo que al método de programación de riego se refiere, los trabajos de investigación hechos por grupos españoles sobre nuevos sensores y aparatos para medir el estado hídrico de la planta figuran entre los más avanzados del mundo.
Básicamente, el riego de precisión se basa en el uso de sensores que miden de forma continua y automática, y que transmiten los datos también de forma automática a nuestro ordenador, tableta o teléfono móvil. Y lo mejor no es eso, sino que se han desarrollado sensores con esas características que son capaces, además, de dar una información precisa sobre el estado hídrico del cultivo, por lo que el agricultor puede determinar con precisión cuándo regar y con cuánta agua. De esa manera, el agricultor puede ver cómo evoluciona el riego, y controlarlo, desde cualquier lugar con conexión a Internet.
De todos los sensores que se han desarrollado, los que mejor información dan son los que miden en la propia planta. El estado hídrico de una planta depende del agua que hay en el suelo, de la demanda atmosférica y de su propio desarrollo y fisiología. Por lo que los sensores que miden en planta la usan como si de un biosensor se tratase, proveyendo al regante información muy útil. Entre estos destacan los sensores, y sistemas relacionados, para medidas de flujo de savia en el tronco (A), de variaciones del diámetro del tronco (B) y del potencial de turgencia en la hoja (C), como los mostrados en la siguiente figura.

¿Qué conseguimos con el uso de esto sensores y, en suma, con el riego de precisión? Pues lograr determinar con exactitud cuál es el punto óptimo en la curva de respuesta de la producción al riego, es decir, el riego que en esta figura aparece como recomendado, y que no es otro que aquél con el que se consigue regar de la forma más rentable para el agricultor y con menos perjuicio para el ambiente. El riego de precisión tiene en cuenta, además, un aspecto muy importante: la variabilidad del suelo y del cultivo.

Casi siempre de riega de manera uniforme para todo el cultivo, independientemente de si algunas zonas son más arenosas que otras, están en pendiente o en llano, etc. El resultado es que suele haber zonas sobrerregadas y otras en las que el agua aportada no es suficiente. Esto se evita con el riego de precisión.
Con este riego, de hecho, los sensores para la medida del estrés hídrico de las plantas se usan en combinación con imágenes aéreas de infrarrojos, como la que se muestra en la siguiente figura. La imagen A es una fotografía de un olivo tomada con una cámara de infrarrojos; los colores definen la temperatura del cultivo. En la imagen B se observa un dron con una cámara de infrarrojos, iniciando el vuelo sobre una plantación de olivar en seto de alta densidad (conocidas popularmente como olivares superintensivos). La imagen C es una foto tomada de dicha plantación, a 40 m de altura, en una zona en la que se aplicaron dos tratamientos de riego, uno abundante (tonos azules) y otro deficitario (tonos naranja).

La información que proveen las imágenes aéreas de infrarrojos permite "ver" las zonas de la plantación con distinta sensibilidad al estrés hídrico, de manera que posibilitan regar "a la carta", suministrándose más agua en aquéllas zonas que tienden a secarse antes y menos en las que, por tratarse de un suelo más arcilloso o similar, necesitan riegos menos abundantes o menos frecuentes. Esto que os cuento no es el futuro; esta tecnología se ha desarrollado ya suficientemente y, si no se usa más por los agricultores, es porque es aún cara y complicada de usar.
La buena noticia es que, por primera vez en la historia de la agricultura, grandes empresas en electrónica y en telecomunicaciones están uniendo sus esfuerzos para producir versiones de estos aparatos baratas y fáciles de usar, para que lleguen a ser de uso habitual entre los agricultores. Como muestra, un botón. Bueno, dos botones: en la figura de la izquierda se muestra uno de estos sensores de nuevo desarrollo, para le medida de potencial de turgencia en hoja. Y, en la de la derecha, se muestra una imagen de una aplicación para teléfono móvil, con las que se transmiten instrucciones sencillas al agricultor para el manejo del riego.

Agradecimientos: Las fotos que aparecen al principio de esta página son fruto de la colaboración del autor con el Dr. Iván García Tejero, del centro IFAPA 'Las Torres - Tomejil' (Junta de Andalucía), y con los Drs. Gregorio Egea y Manuel Pérez Ruíz (Escuela Técnica Superior de Ingeniería Agronómica, Universidad de Sevilla). Las fotos al pie de esta página son fruto de la colaboración del autor con Robert Bosch España SLU y con el Dr. Julio Frías Martínez, consultor y gerente de Aquamática. El autor agradece la financiación recibida por la Junta de Andalucía, el Ministerio de Economía, Industria y Competitividad y los Fondos FEDER, para la realización de sus trabajos. Igualmente, agradece la colaboración de Internacional Olivarera SAU (Interoliva), por la cesión de su plantación en la finca Sanabria para el desarrollo de proyectos de investigación.
José Enrique Fernández
Doctor Ingeniero Agrónomo
Director del Instituto de Recursos Naturales y Agrobiología de Sevilla IRNAS CSIC
Yo siempre quise ser como Nicolás. ¡El Pequeño no! Ese vino después[1]. Quise ser como el original, el auténtico: Nicolás Flamel. Ése que hace casi 700 años dejó atrás la pequeña librería que regentaba en París, y persiguiendo las ilusiones transmitidas por un ángel que se le había aparecido en sueños, se marchó en busca de la Piedra Filosofal, la que le daría las claves para poder convertir cualquier metal en oro y gozar de la vida eterna. Cuenta la leyenda que lo consiguió, que amasó una importante fortuna transformando mercurio en oro y que tras su muerte, los que profanaron su tumba en busca de la Piedra no encontraron rastros ni de la Piedra ni de su cuerpo. Quien sabe… puede que aun esté entre nosotros. Unos cuantos siglos después, los misterios que rodearon a Nicolás y a otros alquimistas de la época siguen siendo eso: misterios. Y la existencia de la Piedra Filosofal, una leyenda. Pero a día de hoy sabemos que la transmutación de la materia (convertir un elemento en otro) es posible. ¡Y no solo eso! Sabemos que es útil. No para enriquecernos. Tampoco para alcanzar la inmortalidad. Pero sí para conocer un poco más acerca de cómo funcionamos, cuándo y por qué enfermamos e incluso cómo curarnos.
La historia de cómo me convertí en alquimista tiene, como todo en la vida, mucho de azar. Dijo John Lennon que la vida es aquello que te pasa mientras estas ocupado haciendo otros planes. Corría el año 2002. Hacía dos días que había defendido mi tesis doctoral y no tenía una idea muy clara de hacia dónde ir. Salió un puesto de trabajo para llevar un ciclotrón. Sin saber aun lo que era eso, solicité el trabajo y me entrevistaron. Una semana después me llamaron para darme el puesto y acepté. Eso ocurrió 20 minutos antes de recibir otra oferta de trabajo en una industria química, que habría también aceptado sin dudarlo y que me hubiera convertido en otra cosa. Dos meses más tarde se rumoreaba que la primera llamada la recibí porque confundieron mi teléfono con el de otro candidato. La suerte se había puesto de mi parte: aun no lo sabía… pero ¡Ya era un alquimista!
El ciclotrón o la Piedra Filosofal
El ciclotrón es la piedra filosofal del S. XXI. Con él transmutamos la materia y su funcionamiento es conceptualmente sencillo. Un ciclotrón de los utilizados más comúnmente es un equipo cilíndrico de unos 2 metros de alto por 2 metros de diámetro que pesa unas 25 toneladas y cuesta algo más de 1 millón de euros. En él se aceleran pequeñas partículas (generalmente protones, partículas subatómicas con carga eléctrica positiva) hasta que alcanzan velocidades de varios miles de kilómetros por segundo.

Fig. 1. Formación de un átomo de 11C mediante bombardeo de un átomo de nitrógeno con protones acelerados. En la parte superior se indican el número de protones (p+) y de neutrones (n) de cada núcleo.
Cuando estas partículas aceleradas colisionan con cualquier material, se produce una reacción muy violenta y dependiendo de las propiedades del material que ha sufrido el impacto, puede darse una reacción nuclear. Así, por ejemplo, si se irradia con protones acelerados un átomo de nitrógeno, elemento que constituye aproximadamente el 80% del aire que respiramos y cuyo núcleo está formado por 7 protones y 7 neutrones, el protón incidente se queda en el núcleo del átomo de nitrógeno y como consecuencia del impacto se emite una partícula alfa (partícula formada por dos protones y dos neutrones). El balance neto global para el átomo de nitrógeno es que pierde un protón y dos neutrones, convirtiéndose en un átomo de carbono-11 (Fig. 1). Nicolás estaría orgulloso… ¡Hemos transmutado la materia!
El átomo de Carbono-11 formado (también notado 11C) tiene un exceso de energía, no se siente cómodo y tiende a pasar de manera espontánea a un estado menos energético. Este fenómeno, que se conoce como radiactividad, va acompañado de la emisión de radiación. En el caso concreto del átomo de 11C el proceso radiactivo conlleva la emisión de un positrón (β+, como un electrón pero con carga positiva), transformando el átomo de 11C en un átomo de boro-11 (Fig. 2a).

Fig. 2. (a) Fenómeno radiactivo por el cual un átomo de 11C pasa a un estado más estable emitiendo un positrón. Nótese que el átomo de 11C se transforma en un átomo de boro. En la parte superior se indican el número de protones (p+) y de neutrones (n) de cada núcleo; (b) el positrón emitido pierde su energía cinética, reacciona con un electrón y desaparece formando fotones gamma.
Nicolás estaría celoso… ¡Hemos transmutado la materia por segunda vez! El positrón emitido colisiona con átomos vecinos y va perdiendo energía cinética (disminuye su velocidad), hasta que se queda prácticamente parado. En este momento reacciona con un electrón, desapareciendo y generando fotones gamma ("luz" de alta energía que nuestros ojos no pueden ver; Fig. 2b).
Nicolás estaría furioso… No sólo transmutamos la materia: ¡La transformamos en energía!
Y todo esto… ¿para qué?
Todos tenemos algún familiar o conocido que padece o ha padecido cáncer. Alguien que un día se notó un bulto en alguna parte del cuerpo, o se empezó a encontrar mal, o perdió visión repentinamente.
También es posible que conozcamos a alguien de avanzada edad que en cierto momento empezó a olvidar cosas, o que simplemente salió de casa y no supo encontrar el camino de vuelta por sí mismo. Síntomas clínicos que, combinados con pruebas médicas, seguramente permitieron establecer un diagnóstico y eventualmente aplicar un tratamiento posiblemente paliativo. Curiosamente, hoy en día sabemos que antes, mucho antes de la aparición de los síntomas clínicos (en ocasiones años), existen alteraciones a nivel molecular que no podemos ver o percibir, pero que están ahí. También sabemos que, una vez diagnosticada una enfermedad y aplicado un tratamiento, la respuesta a dicho tratamiento empieza también a nivel molecular, y se traduce posteriormente en una mejora de los síntomas clínicos. Y podríamos preguntarnos: Si fuéramos capaces de detectar esas alteraciones moleculares, ¿podríamos detectar las enfermedades mucho antes y en consecuencia conseguir que los tratamientos fueran más efectivos? Y ¿podríamos ver de manera mucho más eficiente si el tratamiento prescrito es efectivo? Las respuestas a estas preguntas son sí y sí, gracias en parte (y sólo en parte) a los alquimistas.
La alquimia y su rol en el diagnóstico clínico
Como se ha explicado anteriormente, los átomos de 11C generados con la ayuda del ciclotrón emiten positrones de manera espontánea, y los positrones acaban generando fotones gamma. Dejando el fenómeno radiactivo aparte, el 11C se comporta exactamente igual que su isótopo estable (el carbono-12 ó 12C), que está presente en todas las moléculas orgánicas que existen. Visto de otra forma, tenemos la posibilidad de coger cualquier molécula orgánica que se nos ocurra y sustituir cualquiera de sus átomos de 12C por un átomo de 11C. La molécula resultante tendrá exactamente el mismo comportamiento químico y biológico que la original, pero gracias a que contiene un átomo de 11C, emitirá rayos gamma. ¡Basta con detectar esos rayos gamma para saber en todo momento dónde está la molécula! Y la detección de esos rayos gamma es hoy en día posible. Actualmente, podemos administrar a un paciente un fármaco que contenga un átomo de 11C, y mediante cámaras especializadas, podemos obtener imágenes 3D que nos permitirán saber en cada momento dónde se encuentra el fármaco. Con esas imágenes, se puede obtener información fundamental para conocer qué pasa dentro de nuestro cuerpo, y si existen alteraciones que puedan asociarse a enfermedades.
Un ejemplo concreto: la Enfermedad de Alzheimer
La Enfermedad de Alzheimer (EA) es una enfermedad neurodegenerativa cuyos síntomas clínicos más habituales son la pérdida de la memoria y de otras capacidades mentales. Sin embargo, muchos años antes de que aparezcan estos síntomas tienen lugar en el cerebro diferentes procesos biológicos, y uno de ellos es la aparición de unos conglomerados de proteína microscópicos denominados placas seniles. En otras palabras… si pudiéramos detectar la presencia de placas seniles antes de la aparición de los síntomas clínicos, podríamos efectuar un diagnóstico mucho más precoz de esta enfermedad. Y es aquí donde entra en juego la alquimia.

Fig. 3.(a) Estructura química de la molécula de [11C]PIB. Nótese que uno de sus átomos de carbono-12 ha sido reemplazado por un átomo de 11C. Por simplicidad, la molécula se representa como una estrella roja en 2c y 2e; (b) representación esquemática de un cerebro afectado por EA (izquierda) y un cerebro sano (derecha). Los puntos negros representan placas seniles; (c) tras inyectar [11C]PIB, éste se acumula en las zonas donde hay alta densidad de placas seniles; (d) Los pacientes son sometidos a un estudio mediante el cual se detectan los rayos gamma procedentes de la desintegración
Los alquimistas (o como se nos llama hoy en día, radioquímicos) generamos 11C y lo utilizamos para preparar una molécula denominada [11C]PIB (Fig. 3a; nótese que uno de sus átomos de carbono es 11C). Esta molécula, que se administrada a los pacientes por vía intravenosa, es capaz de pasar de la sangre al cerebro y unirse a las placas seniles. Por lo tanto, aquellos cerebros afectados por EA (que contienen un gran número de placas seniles) tenderán a acumular mucho más las moléculas de [11C]PIB que los cerebros sanos (Fig. 3b y 3c). El 11C, integrante de la molécula de [11C]PIB, sufrirá la desintegración radiactiva con la consecuente emisión de positrones y finalmente de rayos gamma, que pueden detectarse con unos detectores especiales denominados cámaras tomográficas (Fig. 3d). La detección de dichos rayos gamma permitirá obtener imágenes que nos ofrecerán información acerca de la concentración de [11C]PIB en cada región cerebral (Fig. 3e), permitiéndonos discernir entre pacientes sanos y pacientes afectados por EA.
La alquimia más allá de la detección de EA
El concepto general de administrar a un paciente (o voluntario sano, o animal de experimentación) una molécula marcada con 11C (o con otro átomo que emita positrones) y obtener imágenes tiene muchísimas aplicaciones que van mucho más allá de diagnosticar enfermedades neurodegenerativas. Esta estrategia se utiliza también para diagnosticar y evaluar la respuesta al tratamiento de muchos tipos de cáncer, enfermedades cardiovasculares, inflamación e infecciones, entre otras. Además, resulta extremadamente útil en el proceso de desarrollo de nuevos fármacos. Por ejemplo, cuando una industria farmacéutica desarrolla una nueva molécula que podría curar alguna enfermedad, es necesario efectuar estudios para determinar cuál es la mejor ruta y pauta de administración, la dosis óptima, la posible toxicidad, las rutas de eliminación, cómo se metaboliza (esto es, como se rompe) el fármaco dentro del cuerpo, etc. Todo esto es posible utilizando la radioquímica… disciplina apasionante que combina conocimientos de química, ingeniería y física y que requiere de la interacción íntima e ininterrumpida con la biología, la farmacia y la medicina. Una disciplina que como tal no se recoge en los programas educativos de enseñanza superior. Una disciplina con más futuro que pasado y que necesita energías renovadas. ¿Te animas?
Notas:
[1] Estudiante español de Derecho, que se hizo célebre cuando fue detenido en octubre de 2014 acusado de diversos delitos.
Jordi Llop Roig
Doctor en Química, Investigador Principal, CIC biomaGUNE
Cuando era adolescente nunca pensé en ser antropóloga porque no tenía idea de que la Antropología existiese: nadie me habló en el colegio de Antropología y en mi casa, donde mis dos padres eran químicos, la investigación se identificaba con la química, la biología, la física o las matemáticas; pero nunca con las ideas que a mí me parecían interesantes para mi futura profesión: periodista, fotógrafa, profesora, trabajadora social o escritora. Así que no solo no se me ocurrió nunca ser antropóloga, sino que tampoco pensé en ser investigadora.

Esta foto la hicieron y revelaron mis hermanos Guillermo del Olmo (hoy día fotógrafo) y Alfonso del Olmo durante mi último curso de colegio: cuando descubrí que existía la Antropología y decidí que me quería dedicar a trabajar como antropóloga.
Sí tenía claro, sin embargo, que quería ir a la universidad porque me gustaba aprender leyendo libros. Aunque no tanto en clase porque me aburría mucho. Cuando fui un poco mayor, me llevaba al colegio los libros que me interesaba leer y los escondía tapándolos con el libro de texto que tocara. Pero interrumpía mi lectura cuando era necesario y voluntariamente cuando los profesores hablaban de algo que me llamaba la atención: cuando contaban anécdotas personales, historias, o discutían ideas.
Me enteré que existía la Antropología justo a tiempo: en el último curso del colegio y justo unos meses antes de tener que decidir qué quería estudiar. Fue gracias a una profesora de Lengua, en una de esas clases en las que se salió de los temas que iban a entrar en el examen de Selectividad (ahora PAU y pronto quién sabe). Me intrigó lo que contó y le pedí consejo para seguir indagando por mi cuenta. Descubrí un mundo en el que quería encajar.
La Antropología es una profesión que busca entender el comportamiento de las personas, no como individuos, sino como seres que viven en sociedad y por lo tanto cómo influyen las demás personas. Hay muchas formas de hacer antropología: buscando huesos de nuestros antepasados (Antropología física), excavando para encontrar los restos que han dejado pueblos antiguos (Arqueología), estudiando las lenguas que hablan y han hablado los seres humanos (Antropología lingüística), trabajando con documentos escritos por nuestros antepasados (Etnohistoria) o interesándose por todos los pueblos que viven actualmente en el mundo, incluido el propio, para investigar cómo la gente soluciona los problemas generales que plantea la existencia y los concretos que tienen que resolver en la vida diaria, de cualquier tipo: económicos, políticos, sobre las enfermedades, la comida, las relaciones con la gente, la reproducción, la muerte, etc. El objetivo es aprender unas personas de las otras (Antropología cultural).
Decidí que lo que a mí me interesaba en concreto era más aprender de las personas vivas que de los antepasados, así que me centré en la Antropología cultural (o social, o social y cultural, no hay acuerdo definitivo en cómo llamarla). Mi decisión estuvo motivada por el hecho de que veía que la Antropología cultural englobaba todos mis intereses sin tener que renunciar a ninguno: podía enseñar como profesora, entrevistar a la gente como hacen los periodistas, hacer fotografías, interesarme por los problemas de la sociedad y escribir. Pero además, la Antropología me permitía incluir otras aficiones que tenía y que nunca había pensado en ellas nada más que como hobbies: escuchar historias, viajar, discutir ideas y aprender idiomas.
Mi primer trabajo como aprendiz de antropóloga lo hice en la Universidad Complutense para mi tesina (similar al Trabajo Fin de Máster de hoy) sobre las Reservas indias en Canadá. Mi objetivo era tan sencillo como tratar de entender qué eran y cómo se habían formado. Para ello trabajé con documentos históricos sobre los tratados firmados con las naciones indias, con normativas actuales del Ministerio de Asuntos Indios e hice visitas a varias reservas. Conseguí dinero para mi viaje a Canadá con un trabajo de bibliografía que me encargó un profesor.
Aprendí que las reservas no son prisiones para los indios como creía, por lo menos desde el punto de vista legal; sino que, al contrario, son pequeños trozos de los antiguos territorios que cedieron en los tratados y donde los que no son nativos no pueden entrar sin permiso de las naciones indias. En la práctica se han convertido en lugares donde no hay suficientes recursos para sobrevivir, ni trabajos, ni prácticamente posibilidades de salir de la pobreza. Pero su condición legal de territorios reservados y al margen de la legislación del país en muchos aspectos ha podido ser aprovechada por algunas naciones indias para conseguir autogobierno (en Canadá) y en algunos casos para instalar casinos millonarios que financian las necesidades y actividades de las naciones indias (en Estados Unidos).
Mi siguiente trabajo, más "profesional", tanto en profundidad como dedicación lo realicé para mi tesis doctoral sobre los argentinos que se habían exiliado en España durante la dictadura de la Junta militar argentina. Para realizarlo obtuve una Beca predoctoral para trabajar en el CSIC. En esta ocasión utilicé las herramientas del trabajo de campo etnográfico que es la metodología principal (aunque no única) de la investigación en Antropología social y cultural: la observación participante y las entrevistas abiertas.
La observación participante consiste en compartir la vida de las personas sobre y con las que trabajamos en la medida de lo posible, no solo observando, sino participando en todas las actividades y recogiendo todo el proceso de forma escrita en lo que llamamos "diario de campo". Las entrevistas abiertas son conversaciones que se mantienen con las personas que nos interesan para preguntarles acerca de sus comportamientos y, sobre todo, las razones de por qué actúan así.
En mi caso se trataba de preguntar a los argentinos exilados por su proceso de exilio: cómo había empezado, por qué habían venido a España y, una vez que acabó la dictadura, porqué habían vuelto a la Argentina o habían decidido quedarse a vivir en España. Para ello, trabajé fundamentalmente en Madrid, aunque también entrevisté algunas personas clave en Cataluña y viajé a Argentina para conocer a las que habían decidido volver después del exilio. De todo ese trabajo, lo que a mí me interesaba especialmente era el tema de la identidad cultural: qué es la identidad cultural, cómo se construye, para qué sirve. Y descubrí que es una herramienta que utilizamos para dar sentido al comportamiento de las demás personas y para poder anticipar, a grandes rasgos, cómo van a actuar; es decir que nos ayuda a dar sentido a nuestro mundo.
Mi tesis doctoral fue el inicio de mi carrera académica y también el comienzo de una larga trayectoria para conseguir un puesto permanente de investigadora en el CSIC. Después de mi beca predoctoral, tuve otra beca postdoctoral de dos años para trabajar sobre inmigración en España, también en el CSIC. Cuando se acabó esa beca, seguí investigando, pero durante dos años no conseguí ningún tipo de financiación, a pesar de intentar varias posibilidades.
Finalmente, uno de los intentos tuvo éxito: El Ministerio de Educación español me concedió una beca en el extranjero de dos años para trabajar sobre el tema de racismo en la Universidad de Harvard, en Estados Unidos. Me trasladé con mi marido y mi hijo a la ciudad de Boston con el objetivo fundamental de aprender qué es el racismo, cómo funciona, para qué sirve y, sobre todo, qué herramientas estaban resultando útiles para desactivar y desaprender los mecanismos racistas que utilizamos en la vida diaria.
Desde entonces he dedicado mi investigación al tema de racismo y trabajado en Sudáfrica, Canadá, Estados Unidos y Austria, pero sobre todo en España.
Actualmente tengo un puesto de investigadora en el Departamento de Antropología del CSIC, y mi investigación sobre racismo la he centrado en la escuela: cómo perciben los adolescentes las situaciones racistas, tanto dentro como fuera del colegio, y, sobre todo, cómo se enfrentan a ellas.
Los dos últimos años los he dedicado (junto con una colega de la universidad) al tema de abandono escolar. Estamos interesadas en averiguar lo que las personas que han dejado de estudiar dicen sobre sus propios procesos. Se trata de entender sus decisiones y lo que les llevó a ellas, comprendiendo su razonamiento y su lógica, aprendiendo a partir de su propia experiencia sin juzgarles. Uno de los objetivos fundamentales es descubrir qué personas vuelven a estudiar una vez que lo dejaron en la adolescencia, por qué regresan a las clases, qué les ayuda hacer este retorno, qué dificultades tienen y cómo se podría facilitar esta vuelta. La respuesta a estas preguntas podría ayudar en el diseño de programas educativos de adultos, en programas de prevención y también a decidir que es necesario financiar.
Las investigaciones que existen hasta ahora sobre este tema suelen estar basadas en estadísticas que asocian el retorno a los estudios con el desempleo, concluyendo que cuando la gente se queda sin trabajo, como ha ocurrido en la reciente crisis económica, se replantea la necesidad de volver a estudiar, en primer lugar porque tienen el tiempo necesario y en segundo lugar porque esperan así mejorar sus expectativas futuras de empleo. Pero nuestra investigación antropológica nos ha permitido darnos cuenta que muchas de las personas que se matriculan en educación para adultos ya tienen trabajo, aunque una gran parte se encuentra sin contrato precisamente porque para conseguir un empleo es obligatorio presentar el certificado de haber terminado la educación obligatoria.
Según las personas entrevistadas, algunos empresarios no lo exigen, "hacen la vista gorda" o les basta la promesa de matriculación en un centro de adultos, y por ese motivo interpretan que las condiciones de trabajo que les ofrecen son más precarias: no están aseguradas o cotizan por la mitad del tiempo trabajado, y los horarios de trabajo son más largos, en turnos cambiantes que exigen a los trabajadores gran flexibilidad.
Estas condiciones de trabajo chocan frontalmente con las normas rígidas de los Centros de Educación de Adultos que exigen asistencia continua en el horario elegido o asignado. De manera que los cambios de turno en el trabajo tienen como consecuencia, con mucha frecuencia, la pérdida de matrícula, que a su vez puede llevar a la pérdida del empleo. Y esta es una de las causas del enorme fracaso de los programas de retorno, pero no se puede apreciar analizando estadísticas que ofrecen un panorama a grandes rasgos.
Mi objetivo por lo tanto es investigar a pie de calle, el día a día de la gente, y de esta forma contribuir a entender con mayor precisión y con mayor complejidad los procesos sociales. La Antropología proporciona el conocimiento y las herramientas necesarias para realizar este tipo de análisis, a pequeña escala, que contribuyen a explicar los porqués del comportamiento humano y nos permite entender por qué la gente hace lo que hace.
Margarita del Olmo Pintado
Doctora en Antropología, Departamento de Antropología, Instituto de Lengua, Literatura y Antropología, CSIC
Vivimos en una sociedad que valora la inversión en investigación en ámbitos como el cambio climático, la detección y freno del Alzheimer, la salud alimentaria y la nutrición…En este contexto, podría parecer que el tema de la investigación arqueológica no es tan relevante. Sin embargo la Arqueología tiene un papel fundamental en la mejora de las condiciones de vida de la sociedad.
Si estás pensando en dedicarte a las Ciencias Sociales y Humanas pero no tienes clara su utilidad, espero que este capítulo sirva para que comprendas que la Arqueología es un instrumento cargado de futuro [1]. Si tienes dudas sobre los estudios que escogerás, verás que la Arqueología es interdisciplinar, lo que te permitirá abordarla desde distintos ámbitos académicos (Geografía, Historia, Biología, Ingeniería, Geología….) y desarrollarla desde diversas situaciones profesionales y administrativas (universidades, museos, empresas públicas y privadas, organismos de investigación, administraciones públicas…). Además, el mundo entero será tu campo de trabajo.
¿De qué se ocupa la Arqueología?
La palabra "arqueología" procede del griego arkhaiologia, "discurso sobre cosas antiguas". Sin embargo, la Arqueología moderna es una ciencia muy joven, de finales del siglo XIX, aunque algunos autores consideran que la década de 1960 marca en realidad el inicio de la disciplina.
Hoy en día la Arqueología se define como la recuperación, descripción y estudio sistemáticos de la cultura material del pasado, como forma de acceder a las sociedades que la construyeron [2]. El término PASADO hay que delimitarlo: la Arqueología NO estudia rocas o dinosaurios. Esos son objeto de estudio de la Geología o la Paleontología. La Arqueología empieza cuando los primeros útiles, reconocibles como tales, aparecen, y abarca hasta el presente: desde el estudio de las primeras sociedades cazadoras recolectoras hasta, por ejemplo, la reciente Guerra Civil Española (Fig. 1).

Fig. 1. Restos de la Guerra Civil, excavados y restaurados en Paredes de Buitrago (Madrid).
Pero, si la Arqueología se ocupa del pasado de la humanidad, ¿en qué modo se diferencia de la Historia? ¿Es independiente de ésta? ¿Cuál es la relación de la Arqueología con la Historia?
Podría decirse (generalizando y sólo con el ánimo de clarificar la cuestión) que la Arqueología y la Historia no se diferencian por su finalidad sino en el objeto en el que aplican la investigación. Como consecuencia, difieren en los instrumentos necesarios para el estudio y en los procedimientos que aplican.
En realidad, cualquier arqueólogo, sea cual sea el punto de partida de su investigación y el método que emplee, es potencialmente un historiador con la misma dignidad que todos los demás. Pero entonces… ¿Qué hace a la Arqueología especial?
La Arqueología, frente a la Historia, intenta conocer aspectos de la cultura del pasado a través de los restos materiales que de ella se conservan.
Esos restos materiales de la actividad humana del pasado (los datos que emplea la Arqueología) son de diverso carácter: incluyen objetos diferentes (como una lasca de sílex, un fragmento de cerámica), restos monumentales (una casa, una ciudad completa), zonas de actividad humana (lugares de enterramiento, canteras, basureros, campos de cultivo) y también elementos ambientales (desde las propiedades químicas o físicas de suelos y sedimentos (Fig. 2) a los restos biológicos de naturaleza vegetal y animal, como polen, carbones, huesos).

Fig. 2. Perfil de un sondeo arqueológico, preparado para analizar suelos y sedimentos (se trata de una terraza agraria de época romana documentada en El Cabaco, Salamanca).
En definitiva, podríamos decir que la Arqueología es más "democrática" que la Historia, ya que se ocupa no sólo de las grandes obras, sino que se interesa también por lo pequeño, por los restos, que aun pareciendo insignificantes, nos pueden decir mucho acerca de cómo eran las sociedades antiguas.
La labor arqueológica está marcada por tres condiciones fundamentales [3]:
-En primer lugar, por las características de los datos: la Arqueología utiliza como datos los efectos intencionales, o no, de la transformación humana del medio natural (actividades de recolección, agrarias, mineras, constructivas…). Sus efectos se registran, normalmente, desvinculados de las relaciones sociales que las originaron.
- En segundo lugar, esos datos que se registran han sido afectados por diversos y complejos procesos de transformaciones (abandono, erosión, destrucción intencionada…).
- En tercer lugar, estas particularidades de la información condicionan tanto los métodos como los problemas teóricos que es necesario resolver para poder sistematizar los procedimientos de investigación. El sentido común no basta: el pensamiento arqueológico no es ajeno a la teoría del conjunto de las Ciencias Humanas y Sociales[4].
En relación con los métodos de la Arqueología, estos van más allá de la excavación e incluyen la prospección, la teledetección o el estudio de la fotografía aérea. Hoy en día tiene mucho peso la investigación arqueométrica, cuyos objetivos incluyen campos como la caracterización de materiales y la datación de objetos y yacimientos arqueológicos. Y todo ello, como comentaba al principio, desde una perspectiva interdisciplinar. La Geografía, la Geología, el Derecho, la Edafología, la Biología, la Ingeniería, etc., se desarrollan en la actualidad como campos de investigación contiguos a la Arqueología.
Uno de los ámbitos más dinámicos de la Arqueología y que refleja muy bien este carácter interdisciplinar es el de la llamada Arqueología del paisaje, que parte del análisis del paisaje actual para el estudio de las sociedades del pasado. El paisaje puede parecer natural, pero en todas partes ha sido modificado por las comunidades humanas, por lo que conserva huellas del pasado remoto y reciente. Se convierte así en fuente de datos para la Arqueología, con informaciones de diversa naturaleza.
Esta idea es fundamental para entender la labor de la Arqueología y romper uno de los mitos más arraigados sobre la actividad arqueológica: la idea de que los arqueólogos son eruditos centrados en la búsqueda de objetos. Este tópico está en realidad muy vinculado con la exposición descontextualizada de piezas en los museos, que conduce al error de que es más importante el dato que la forma o el contexto en el que se ha recogido.
Por otra parte, esto tiene enormes implicaciones para la conservación y gestión del patrimonio arqueológico en el marco de las políticas de planificación territorial. Sin embargo, la división de competencias administrativas hace que esto no siempre sea tarea fácil.
Pero, ¿cuál es la utilidad de la Arqueología en una sociedad como la actual?
Hemos visto que nuestro entorno, los paisajes, los yacimientos arqueológicos, los restos exhibidos y salvaguardados en los museos… son el pasado tangible y visible. Nuestra memoria, nuestra alma. La Arqueología tiene una enorme responsabilidad frente a su protección y su conservación.
Por otra parte, la Arqueología se ocupa de la narración y comunicación de las historias producidas por la investigación arqueológica, sirve "para producir conocimiento histórico de todas las sociedades pasadas, de todos sus miembros, desde planos de igualdad y respeto" [1]. El arqueólogo británico Graham Clark decía que la Arqueología puede ser más democrática que buena parte de la Historia, porque su objeto de estudio es toda la sociedad: los poderosos y los débiles, los ancianos y los niños, los hombres y las mujeres. Todos se pueden rastrear en la materialidad social.
Por último, la Arqueología tiene un papel fundamental en la supervisión atenta y crítica de como esos conocimientos se utilizan en el marco de nuestra sociedad [1]. Entre esos usos del pasado quizás el más llamativo es el caso de los nacionalismos. El nacionalismo en Arqueología se manifiesta hoy de muchas maneras, por ejemplo en la idea legítima de que los descendientes de una determinada cultura tienen un mayor derecho que los demás a investigar e interpretar sus restos. Más alarmante es la creación de identidades excluyentes sobre elementos del registro arqueológico, que se utilizan para diferenciar colectividades y dotarlas de profundidad histórica. En otros casos, la Arqueología se utiliza para destruirlas, como se ha visto en los recientes ataques a sitios arqueológicos del norte de Irak, en lo que se ha dado en llamar una "yihad" arqueológica del Estado Islámico que ha provocado la pérdida de ciudades antiguas como Nimrud, Hatra o DurSharrukin.
Para saber más sobre la Arqueología existen muchos libros de gran calidad. Puedes comenzar con dos (números [5] y [2] de las referencias). Verás que la Arqueología, como todas las Ciencias Humanas y Sociales, no es una ciencia "fácil" y que, para dedicarse a ella, hay que ser una persona valiente, con gran sentido crítico, que sepa vincular continuamente el pasado y el presente. Solo así, lograremos que la Arqueología contribuya a la construcción de un futuro libre de los sectarismos impuestos por el pensamiento único actual.
Referencias:
[1] G. Ruiz Zapatero, 2014, "Arqueología: Abrir ojos cada vez más grandes", Arqueoweb, Vol. 15, Nº. 1 (texto completo en dialnet.unirioja.es).
[2]. V. Fernández Martínez 1989, Teoría y método de la arqueología.
[3].L. F. Bate, 1998, El proceso de investigación en arqueología.
[4].M. Johnson, 2002, Teoría arqueológica: una introducción.
[5] P. Bahn, 1998, Introducción a la Arqueología.
María Ruiz del Árbol Moro
Doctora en Historia Antigua
Científica Titular, Instituto de Historia, CSIC
Comenzaré por decir que tengo 54 años, así que algunas de las situaciones que voy a describir puede que les resulten extrañas a los jóvenes de esta época. Sin embargo, me atrevo a pensar que, aunque parezca que el mundo y los humanos han cambiado muchísimo desde la época en la que yo era una niña, en realidad lo que ha cambiado han sido más las formas que lo esencial. Seguimos teniendo deseos y sentimientos parecidos y, entre ellos, creo que hay uno muy poderoso, que es el de poder realizar una actividad profesional que trascienda el objetivo de ganar lo necesario para vivir dignamente y nos haga disfrutar a un nivel profundo. Entre los trabajos que ayudan a cumplir este deseo están aquellos que fomentan el desarrollo de nuestra creatividad, los que nos impulsan a pensar y a no repetir mecánicamente los procesos diseñados por otros. Aquí estaría el lugar de las artes, de la literatura, del diseño, y, por supuesto, también el de la ciencia.
Sin embargo, yo no nací con la vocación de ser astrobióloga. Ni siquiera con la vocación de ser científica. De hecho, de niña, casi ni me planteaba lo que quería ser de mayor. Nací en un pueblo pequeño y allí pasé mi infancia. En ese lugar y en esa época, los hombres iban al campo y las mujeres, con la honrosa excepción de las maestras, no trabajaban fuera de la casa. Si me hubieran preguntado qué quería ser de mayor, habría dicho primero que ama de casa y luego, si necesitaba trabajar, pues maestra. Eso era lo que se esperaba de mí y yo no me cuestionaba que pudiera ser de otra manera. En esa época disfrutaba mucho de la naturaleza, pero no me planteaba demasiadas preguntas sobre el mundo que me rodeaba. Lo que sí que me llamaba mucho la atención era que los médicos pudieran curar las enfermedades. Que hubiera pastillas o jarabes capaces de corregir lo que funcionaba mal en las personas era algo que me fascinaba. No me asombraba tanto que el enfermo se curara, sino el milagro que hacían esas sustancias dentro de su cuerpo. Supongo que esa fue mi primera inquietud como investigadora, que en algún momento confundí con una vocación médica que ahora veo claro que no tenía.
Unos pocos años más tarde, llegué a Madrid para hacer el bachillerato, que normalmente se cursaba entre los 14 y los 18 años. Entonces fue cuando comenzaron a perfilarse los intereses que han marcado mi vida. Concretamente, recuerdo una clase de química en la que la profesora nos dijo algo que puede parecer obvio, pero que a mí entonces me supuso una revelación sorprendente y es que los seres vivos y los no vivos estamos hechos de los mismos elementos, que no hay nada mágico en la materia viva, más allá de la diferente organización de esos elementos. A partir de ese momento comencé a plantearme preguntas que nunca antes me había hecho: ¿Qué clase de "programa" puede organizar la materia para que los seres vivos puedan realizar todas esas funciones que los diferencian tan claramente de los no vivos? ¿Por qué algunos seres vivos son capaces de dividirse y poco más mientras que otros son, incluso, capaces de pensar y reflexionar sobre sus propios pensamientos? ¿Por qué hay seres vivos tan distintos cuando, a nivel molecular, todos ellos se parecen tanto? Todos tienen proteínas, tienen ácidos nucleicos, y, sin embargo, con el mismo material ¡cuántas diferencias pueden surgir! Poco a poco, me di cuenta de que quería conocer más y más sobre este tema: ¿Cómo surgió la vida? ¿Cómo se dio ese paso de la química a la biología? ¿Cómo fue aumentando la complejidad en biología? ¿Cuáles son los mecanismos que han permitido que, a partir de la primera célula viva, surja toda la diversidad biológica que existe actualmente? Así, dejé de querer ser maestra y empecé a querer ser bióloga. Quería saber más sobre la vida, sobre sus orígenes, sobre su evolución… En último caso, pensé que podría ser profesora de biología, y así contentaba a todos, a mi familia que quería que fuera maestra y a mí misma, que me veía bióloga. Pero lo que sucedió, mientras estudiaba la carrera de Biología, es que me di cuenta de que quería hacer algo más que transmitir los conocimientos que yo aprendía. Enseñar me gustaba, no lo voy a negar, pero además, yo quería generar conocimiento. Y entendí que para eso no me quedaba otra opción que la de salirme del camino marcado, ponerme la bata blanca y meterme en un laboratorio. Podéis pensar que tampoco me salí mucho del camino, y tenéis razón. Pero también es cierto que esa decisión supuso cierto coraje, al renunciar a vivir la vida que los demás me aconsejaban, iniciando en cambio mi propia ruta. Y eso no siempre es fácil.
Cuando acabé la carrera me empeñé en buscar un laboratorio en el cual aprender el método científico y aplicarlo a un tema de investigación concreto.
Tuve mucha suerte, obtuve una beca para realizar un doctorado en el Centro de Biología Molecular Severo Ochoa. El tema asignado para mi tesis no se parecía mucho a lo que eran mis intereses más profundos, pero no me importó. La verdad es que en los cinco años de mi carrera, jamás había oído la palabra Astrobiología y yo no tenía muy claro dónde dirigirme para investigar en ese campo. Sin embargo, el simple hecho de poder experimentar cómo era el trabajo científico durante los cuatro años que suele durar un doctorado, ya me parecía un gran logro. Y lo cierto es que, cuando uno se mete en un tema e intenta aportar en él lo mejor de sí mismo, te acaba gustando y yo no fui una excepción en esto. Pero a mí me seguían interesando las cuestiones que ya he comentado y me iban surgiendo otras nuevas: ¿Podría haber vida en otros planetas del sistema solar o incluso fuera de él? ¿La vida tendría que estar basada necesariamente en ácidos nucleicos y proteínas? ¿Podría haber otras moléculas que almacenaran la información genética? ¿Las funciones biológicas tienen que ser necesariamente llevadas a cabo por las proteínas? Y así empecé a darme cuenta de que tenemos muy claro lo que es la vida, pero eso solo es cuando no nos salimos de los límites de lo conocido. En cambio, no tenemos ni idea de cómo podría ser la vida en otro planeta, ni siquiera de si seríamos capaces de reconocerla. Y así, dándole vuelta a esas cuestiones, un día mirando el periódico me entero de que están buscando científicos para un nuevo centro de investigación llamado "Centro de Astrobiología", que se va a dedicar al estudio del origen y evolución de la vida en el Universo. ¡Casi no me lo podía creer! Y menos aún me creía que mi currículum pudiera interesar en un centro como ese, que decían que estaba asociado a la NASA. Reconozco que necesité un pequeño empujón de algunas personas para animarme a presentar una solicitud. Cómo no tenía nada que perder, decidí que, en lugar de escribir un currículum que resaltara mis méritos académicos y profesionales, lo que haría sería describir mi pasión. Hablé sobre las preguntas que me habían motivado a estudiar biología, sobre mis intereses, sobre mi motivación a adentrarme en nuevos terrenos. No dije "quiero ser astrobióloga", pero lo que describí se parecía mucho a eso. El final es feliz, me contrataron en el Centro de Astrobiología… ¡y aquí sigo! Mi trabajo consiste en realizar estudios de evolución experimental, para lo cual trabajo con virus y microorganismos. Los experimentos que realizamos en mi grupo, básicamente consisten en propagar una población ancestral, que tenemos bien caracterizada, en ciertas condiciones que imponemos y controlamos nosotros. Con el paso del tiempo, se genera una población evolucionada, que analizamos y comparamos con la ancestral. De este modo, intentamos no solo encontrar cómo los seres vivos se adaptan a condiciones concretas, sino también extraer conclusiones generales sobre el proceso evolutivo.
Y sigo también con la pasión de enseñar, tanto en el ámbito académico como fuera de él. Creo que la gente quiere saber sobre ciencia, quiere entender el mundo que les rodea y, si los científicos podemos ayudarles, en cierto modo estamos obligados a hacerlo. A fin de cuentas, es la sociedad, quien con sus impuestos, paga nuestras investigaciones. A día de hoy, no sé qué es lo que me hace más feliz si el trabajo científico o el trabajo de divulgación. La divulgación tiene un lado humano que es muy gratificante y que no siempre encuentro en el trabajo puramente científico, así que mi aspiración es seguir haciendo ambas cosas durante todo el tiempo que pueda y los demás me lo permitan.
Ester Lázaro
Doctora en Ciencias Biológicas, Investigadora científica, Departamento de Evolución Molecular, Centro de Astrobiología (CSIC-INTA), Madrid
¡Quién me iba a decir, allá por el año 1985 cuando empecé mis estudios de Bachillerato en lo que se llamaba "Ciencias Puras" y tras mi licenciatura en Ciencias Químicas (especialidad Química Física), que desarrollaría mi carrera profesional investigando en el ámbito de la Química Física de la atmósfera terrestre y del medio interestelar!

Fig. 1. Moléculas prebióticas detectadas en el medio interestelar posibles precursoras de bases del ARN y ADN.
Pues sí, la vida da muchas vueltas. Y hablando de vida... mucho se ha especulado sobre el origen de la vida en nuestro planeta. Existen diversas teorías desde la teoría de la sopa o caldo primordial propuesta por el bioquímico ruso Aleksandr I. Oparin en 1924 hasta que las moléculas prebióticas vinieron del espacio (Panspermia) [1]. En 1953 Stanley Miller y Harold C. Urey llevaron a cabo un experimento donde se comprobó que se sintetizaban aminoácidos a partir de una disolución acuosa de amoníaco, metano e hidrógeno sometida a una descarga eléctrica [2]. Lo que es evidente es que las condiciones ambientales de la Tierra (temperaturas moderadas, agua líquida, atmósfera de oxígeno, etc.) han propiciado la existencia de vida en nuestro planeta. La Panspermia, por otro lado, se centra en la idea de que las moléculas prebióticas llegaron a la Tierra desde el Espacio a través de meteoritos y otros objetos.
Este capítulo no pretende discutir qué teoría es la correcta, ya que es un debate abierto y vivo aún en la actualidad, si no pretende despertar vocaciones científicas y acercar a jóvenes promesas la química en fase gaseosa de compuestos orgánicos simples que puede dar lugar a nuevas especies en el medio interestelar.
¿Qué es el medio interestelar y de qué está compuesto?
El medio interestelar es la materia que existe entre dos sistemas estelares. El sistema estelar más cercano al nuestro es Alfa Centauri que se encuentra a unos 4.37 años-luz (1), es decir, más de 40 billones de km y que posee tres soles. Aunque uno puede pensar que el espacio está "vacío", no es así. El medio interestelar está formado principalmente por H2 y He en aprox. un 98-99% (en masa), el resto es polvo estelar, además la radiación (rayos cósmicos, rayos X, radiación ultravioleta, etc.) invade este medio. Las condiciones físicas del medio interestelar cubre un amplio intervalo de temperaturas (T) y densidades moleculares (número de partículas por cm3, n). En la región más fría del medio interestelar, T=10−100 K (2), entre -263 ºC y -163ºC se encuentran las denominadas nubes moleculares densas, debido a su alta densidad de entre 20 y un millón de átomos/cm3.
Como veis, todo es relativo y lo que en la Tierra es "ultrafrío" en el medio interestelar es "frío". Lo que en la Tierra es "vacío" en el medio interestelar es algo "denso". De hecho, ni con el mejor vacío que se puede conseguir en la Tierra, si usáramos una bomba de vacío que pudiera evacuar todo el aire que hubiera en un recipiente, no llegaríamos nunca a conseguir las densidades de ciertas partes del medio interestelar. Esto hace que simular en el laboratorio las condiciones de densidad del medio interestelar sea imposible. Respecto a la temperatura, nos encontramos con el problema de obtener gases a temperaturas a las cuales serían sólidos en la Tierra ya que condensarían.
Astroquímica: Observación versus Experimentación en Laboratorio
La Astroquímica es una rama de la Astronomía y la Química que estudia la composición y la evolución química del Universo. Por tanto, esta rama del saber incluye tanto la observación del espacio mediante radiotelescopios como la experimentación en el laboratorio simulando las condiciones del mismo. El apoyo de los modelos astroquímicos y la computación permiten tener un mejor conocimiento de lo que ocurre a años-luz de nosotros.
Aunque la composición principal del medio interestelar es H2 y He, existen también especies orgánicas que contienen otros elementos químicamente activos y abundantes en el Universo, como son C, O, N y S. Hasta el momento, se han detectado en el medio interestelar más de 180 especies (radicales, moléculas e iones) [3]. En esta región del espacio se han observado moléculas diatómicas como el radical hidroxilo (OH), triatómicas como el agua (H2O), o moléculas orgánicas más complejas que encontramos en nuestra vida diaria como metanol (CH3OH), etanol (CH3CH2OH), acetona (CH3C(O)CH3) e incluso fulerenos de 60 y 70 átomos de carbono. Las abundancias de estas especies interestelares se suele expresar relativas a la abundancia total de átomos de H (H2 + H atómico) y suelen ser muy pequeñas. Sin embargo, aun siendo muy poco abundantes la química de estas especies juega un papel esencial en la síntesis de otras moléculas más complejas en el Espacio. Para interpretar las abundancias relativas observadas por astrónom@s para éstas y otras especies que se formen a partir de ellas, se deben introducir en los modelos astroquímicos datos de la velocidad de todos los procesos de eliminación/formación en los que están implicadas tanto en las superficie de los granos de polvo como en fase gaseosa.
Centrémonos, aquí, en la química en fase gaseosa que ocurre en las nubes moleculares densas, ya que es ahí donde se forman nuevas estrellas y donde se han detectado la mayoría de las especies orgánicas anteriormente citadas. Desde el punto de vista experimental, conseguir moléculas en estado gaseoso a las temperaturas típicas de estos entornos ultrafríos (10-100 K) es un reto, ya que se debe evitar la condensación del gas y la formación de gotas de líquido. Por ejemplo, en la Tabla 1 se presenta el punto de fusión, es decir, la temperatura a la cual se encuentran en equilibrio el sólido y el líquido, de algunos compuestos oxigenados a presión atmosférica. El punto de fusión, a diferencia del punto de ebullición, no se ve afectado significativamente por la presión. Además, para la mayoría de los compuestos el punto de fusión y de congelación son iguales. Por eso, a las temperaturas de nuestro planeta estas especies orgánicas son líquidos. Como vemos en la Tabla 1, estas especies serían sólidos entre -173 ºC y -263 ºC si se enfriara el gas en equilibrio con el líquido, mediante recirculación de un líquido refrigerante por el exterior del reactor. Cuando ese líquido es N2 (a 77,36 K º−195,79 °C) o He (a 4,22 K º −268,93 °C) se denomina criogenia.
| Tabla 1. Puntos de fusión (o de congelación) [4]. | |||
| Compuesto | Tfusión/ ºC | Compuesto | Tfusión/ ºC |
| H2O | 0 | CH3C(O)CH3 | -95 |
| CH3OH | -97,6 | CH3OCH3 | -141 |
| CH3CH2OH | -114,1 | CH3CHO | -123,5 |
Sin embargo, Bertrand Rowe y col. en los años 1980's inventaron la técnica CRESU (acrónimo de Cinética de Reacciones mediante Expansión Supersónica Uniforme) que permite obtener una temperatura ultrabaja uniforme del gas (hasta 6 K!!!) y estudiar la velocidad de reacciones ion-molécula o radical-molécula, ya que se consigue también una uniformidad en la densidad molecular. Esto supuso un gran avance científico, ya que podían estudiarse reacciones de interés astroquímico y observar su comportamiento a las temperaturas típicas del medio interestelar. Hace unos meses, tuve el honor de publicar un artículo junto a B. Rowe, donde revisábamos los más de 30 años de esta técnica y sus perspectivas de futuro [5]. A pesar del potencial de esta técnica, menos de una decena de grupos de investigación la emplean con este fin en todo el mundo. Uno de esos grupos es el del departamento de Química Física de la Universidad de Castilla-La Mancha en Ciudad Real.
Nuestro sistema CRESU es el más potente en la actualidad en su categoría (que pulsa el gas para economizar gastos y capacidad de bombeo) y somos capaces de alcanzar temperaturas entre 13 K y 107 K. Iniciamos nuestra andadura en 2012, pero un complejo sistema de estas características que debe diseñarse, construirse y poner a punto por nosotros los investigadores, no se desarrolla en un año ni en dos.

Fig. 2. Fotografía del CRESU de la Universidad de Castilla-La Mancha en Ciudad Real. Único en España y el más potente de su categoría en el mundo.
Hay que ensamblar diversa instrumentación, como láseres pulsados que emiten radiación ultravioleta, aparatos electrónicos que controlan la introducción de los gases en el reactor, aparatos ópticos para detectar la especie de control cinético (en nuestro caso, el radical OH), y un largo etc. En la fotografía de la Fig. 2 se puede ver la complejidad del mismo y se puede hacer el símil con una orquesta sinfónica: si algún instrumento desafina, el concierto se va al garete y no obtenemos resultados correctos o, en el peor de los casos, no se puede obtener ningún dato. Tras conseguir que la orquesta bien afinada, en 2015 empezamos a publicar nuestros resultados sobre las reacciones entre el radical OH (detectado en 1963 en el medio interestelar) y especies interestelares como metanol [6], formiato de metilo [7] y recientemente formaldehído, H2CO [8].
La reactividad de OH con estos compuestos orgánicos se ha confirmado experimentalmente que es de uno a varios órdenes de magnitud superior a lo observado a temperaturas típicas de la atmósfera terrestre, donde la base de datos cinéticos es muy amplia y los parámetros que rigen la reactividad de OH están bien establecidos. Esto tiene grandes implicaciones en la interpretación de las abundancias observadas astronómicamente, ya que en ausencia de datos cinéticos a T<100 K, si se consideran las constantes de velocidad a temperaturas superiores en los modelos astroquímicos, se puede subestimar la velocidad a la que se forman otras especies en fase gaseosa como el radical metoxilo, CH3O, formado en la reacción con metanol [6] o el radical formilo, HCO, formado en la reacción con formaldehído [8]. Este comportamiento ha de ser confirmado para otras reacciones en fase gaseosa, y no solo con el radical OH sino con otras especies radicálicas de interés astroquímico como los radicales carbonados CN, CH, C2H, etc. Por lo que seguimos trabajando en ello en nuestro grupo de investigación.
En conclusión…
La Astroquímica está experimentando grandes avances en las últimas décadas debido al desarrollo tecnológico de los radiotelescopios que ha permitido identificar muchas especies en estos entornos astrofísicos ultrafríos cuya química no es conocida. Como química, creo que este ámbito va a proporcionar muchas respuestas sobre la formación de nuevas moléculas, algunas de ellas, precursoras de la vida tal y como la conocemos en nuestro planeta. Como dijo Don Quijote de la Mancha: "Parece, Sancho, que no hay refrán que no sea verdadero, porque todos son sentencias sacadas de la mesma experiencia, madre de las ciencias todas."
Entonces, quieres "experimentar" y ser Astroquímic@?
Notas:
(1). 1 año-luz es la distancia que recorre la luz en el vacío en un año, es decir, @9,46×1012 km.
(2). Equivalencia de temperaturas: T(K) = 273,15 + T(ºC)
Referencias:
[2] Stanley L. Miller (1953). "A production of amino acids under possible primitive Earth Conditions". Science 117: 528-529.
[4] David R. Lide (2009). CRC Handbook of Chemistry and Physics (90 edición).
[5] Alexey Potapov, André Canosa, Elena Jiménez, Bertrand Rowe. (2017) Angew ChemInt Ed. 56(30):8618-8640.
[6] María Antiñolo, Marcelino Agúndez, Elena Jiménez, et al. (2016) Reactivity of OH and CH3OH between 22 and 64 K: modelling the gas phase production of CH3O in Barnard 1B. Astrophys. J. 823(1):25.
[7] Elena Jiménez, María Antiñolo, Bernabé Ballesteros, André Canosa, José Albaladejo. Phys.Chem.ChemPhys. 2016 18(3):2183-91.
[8] Antonio J. Ocaña, Elena Jiménez, Bernabé Ballesteros, et al. (2017) Kinetics and dynamics of the OH+H2CO reaction at temperatures of the interstellar medium (ISM): Experiments, theory and modelling of the HCO formation in the ISM.Astrophys. J. En prensa.
Elena Jiménez
Doctora en Ciencias Químicas
Profesora Titular de la Universidad de Castilla-La Mancha
Debo ser sincero. Yo, en realidad, no quería ser astroquímicos. Ni astrofísico, ni físico. O mejor dicho, no sabía que quería serlo. Nunca tuve una verdadera vocación por la astronomía. Decidí estudiar física pocos meses antes de iniciar la universidad, y acabé dedicando mi tesis doctoral a la astrofísica por azares del destino.

Fig. 1. Izquierda: Estructura de adenosín trifosfato (ATP; C10H16N5O13P3). Imagen de Ben Mills. Derecha: estructura de doble hélice del ácido desoxirribonucleico (ADN). Imagen de Richard Wheeler. Las esferas de colores indican átomos de distintos elementos químicos: hidrógeno (blanco), oxígeno (rojo), nitrógeno (azul), carbono (gris) y fósforo (naranja).
Pero el caso es que fue así, de lo cual ahora me alegro mucho. Durante mis años en el Centro de Astrobiología de Madrid, estudié en mi tesis cómo se distribuyen las estrellas en las zonas del cielo donde se forman las estrellas más masivas.
Simplificando un poco, me dediqué a contar estrellas en el cielo. Y después me mudé a Florencia, al observatorio de la colina de Arcetri, un enclave casi sagrado para un astrofísico, porque es allí donde Galileo transcurrió sus últimos años de vida. Y aquí, en Florencia, me adentré verdaderamente en el mundo de la astroquímica. ¿Y qué es la astroquímica? En pocas palabras, es la ciencia que estudia cómo se forman las moléculas en el espacio. ¿Y por qué queremos saber esto? La respuesta es simple: para satisfacer nuestra infinita curiosidad como científicos y entender de dónde venimos. Todo aquello que vemos a nuestro alrededor, incluido nosotros mismos, está constituido por átomos que se agrupan formando moléculas. Moléculas simples como el oxígeno molecular (O2) que respiramos en nuestra atmósfera, o el agua de nuestros océanos (H2O). Moléculas algo más complejas, como el etanol (C2H5OH) que bebemos en una copa de vino o el etilenglicol ((CH2OH)2), que usamos como anticongelante en nuestros coches. Y moléculas aún más complejas, como el adenosín trifosfato (ATP; C10H16N5O13P3, Fig. 1), que es la principal fuente de energía para las células, o como el ácido desoxirribonucleico (ADN), la doble hélice que almacena nuestra información genética (Fig. 1). Las moléculas son los ladrillos que construyen toda la materia, y en particular los seres vivos. Estamos hechos, sobre todo, de átomos de hidrógeno, carbono, oxígeno, nitrógeno, azufre y fósforo. A partir de estos ingredientes básicos surgió la vida en nuestro planeta durante los primeros pasos de nuestro sistema solar. ¿Cómo estos elementos, que formaron las primeras moléculas, llegaron hasta la Tierra primigenia? Para encontrar la respuesta, al igual que hizo Galileo hace siglos, debemos alzar nuestra vista hacia el cielo…
Nuestro sistema solar se formó, junto con otras estrellas, hace unos 4500 millones de años, a partir de una enorme nube de moléculas y de pequeños granos de polvo. Por efectos gravitatorios, una parte de esta nube colapsó sobre sí misma, dando lugar a un disco de material rotante.

Fig. 2. Imagen artística de moléculas de isocianato de metilo (CH3NCO) en una región de formación estelar, IRAS16293-2422, similar a como pudo ser nuestro primigenio sistema solar. Imagen de ESO/L. Calçada.
En su centro se formó una estrella, nuestro Sol, mientras que en el disco fueron naciendo los planetas, las lunas, los asteroides, y los cometas. Como astroquímicos, nuestro trabajo consiste en estudiar la complejidad química en el que todo nuestro mundo tuvo su inicio. Para hacerlo, visto que no podemos viajar al pasado, al momento del nacimiento del nuestro sistema solar, utilizamos dos estrategias diferentes. La primera consiste en estudiar regiones donde cuerpos parecidos a nuestro sistema solar se están formando ahora. Un ejemplo de estos análogos a lo que fue nuestro joven sistema solar es la región IRAS 16293-2422, donde hemos detectado una multitud de moléculas simples claves para la vida, como el isocianato de metilo (CH3NCO; Fig. 2), importante para formar proteínas, o el glicolaldeído (CH2OHCHO), la forma de azúcar más simple. Por tanto, hemos aprendido que moléculas que juegan un papel muy importante en la química de la vida están ya presentes en la nube de gas que formará un sistema solar parecido al nuestro.

Fig. 3. Imagen del cometa 67P Churyumov-Gerasimenko tomada por la sonda Rosetta el 7 de Julio de 2015.
La segunda forma de investigar cómo pudo ser la química de nuestro sistema solar es observar objetos celestes que apenas hayan sufrido alteraciones desde el momento de su formación. Estos objetos que nos ofrecen material prístino del origen del sistema solar son los cometas. Recientemente, la misión Rosetta de la Agencia Espacial Europea (ESA) ha completado un apasionante viaje hacia el cometa 67P Churyumov-Gerasimenko (Fig. 3), y nos ha proporcionado información esencial acerca de su composición química. Sus instrumentos han descubierto que elementos básicos para la vida, como el fósforo y la glicina - el aminoácido más simple - estaban ya presentes en las primeras etapas de nuestro sistema solar. Estos ingredientes pudieron ser transportados hasta la Tierra primigenia mediante una intensa lluvia de cometas que impactaron contra el planeta, portando consigo las moléculas básicas que formaron los primeros organismos vivos.
Sea de la nube molecular natal, sea gracias al impacto de múltiples cometas, está claro que nuestra herencia química viene del cielo. Y a eso me dedico ahora, a mis 32 años. Y me resulta curioso, diría que casi increíble, que hace 16 años, cuando era un adolescente que desconocía que acabaría estudiando física, astronomía, astroquímica o astrobiología, escribí un pequeño relato en el que todos estos elementos ya estaban allí… Trata sobre un niño cuya curiosidad le lleva a observar el cielo todas las noches y a contar las estrellas… exactamente como acabaría haciendo yo en mi tesis. Pero una noche, una de las estrellas desaparece misteriosamente. En su búsqueda, el niño descubrirá, sin entrar en detalles para no anticipar el final del cuento, que el cielo esconde las claves de nuestro propio origen. Visto con la perspectiva del tiempo, parece como si siempre hubiera querido ser astroquímico… sin yo saberlo. Por ello, no se me ocurre mejor manera de terminar este capítulo que con esta pequeña historia de un niño y una estrella. Espero que disfrutéis con su lectura.
* * *
El niño, tumbado en la fría arena de la playa, observaba maravillado el oscuro manto celeste. Una constelación allí, otra allá. El niño las miraba, deleitándose en la lejana y majestuosa belleza que irradiaban aquellos diminutos puntos de luz y fuego. Contaba las estrellas: una, dos, tres, cuatro..., cuarenta y dos, cuarenta y tres... No se cansaba nunca. Al contrario, se sentía cada vez más despierto, ensimismado por la bóveda de naturales bombillas que le envolvía, con los ojos tan abiertos como podía, intentando captar cada partícula, cada minúsculo detalle del paisaje nocturno. Cincuenta y cuatro, cincuenta y cinco... Entonces cesó de contar y arrugó contrariado su rostro. Retrocedió y volvió a enumerar las estrellas. Una, dos, tres..., cincuenta y cuatro, cincuenta y cinco..., se detuvo de nuevo. "No puede ser", pensó, "Falta una". En el lugar de la quincuagésima sexta estrella no había más que un negrísimo pedacito de cielo. El niño conocía el mapa celeste mejor que cualquier otra cosa. Había estudiado desde pequeño libros y libros de astronomía que su padre le traía de la biblioteca del pueblo. Pasaba noches enteras en la playa, sin dormir, inspeccionando cada pulgada de la inmensidad que sobre él se extendía. Repasó la enumeración con cuidado, esperando encontrar el punto de luz perdido. Pero allí no estaba.
No podía creérselo. ¿Cómo era posible? ¿Aquella estrella había escapado de su natural ubicación? ¿Su brillo inagotable se había extinguido? El niño estaba terriblemente confuso. La perfecta armonía que admiraba cada noche acababa de quebrarse. Aquella misteriosa desaparición rompía en pedazos, delante de sus ojos, la condición eterna que había otorgado a los astros. Se había convencido de que todo el mal que acechaba al mundo terrenal nunca podría perturbar un solo átomo de lo que había arriba, un mundo más bello, más apacible. Siempre había creído en la incorruptibilidad del mundo celeste, en su perpetua y divina ordenación. Pero ya no podía estar seguro de eso, una estrella se había perdido, y podría ser sólo el primer paso hacia un abismo. Tenía mucho miedo. Y frío. Tiritaba cada vez más. La brisa era gélida. Por primera vez, se sentía muy solo en la playa. Quería levantarse, marcharse de allí. Pero no podía moverse, tenía las piernas atenazadas. Miró hacia el horizonte. La noche no permitía distinguir la línea entre cielo y océano. Las aguas estaban tranquilas. La luz de la media luna coloreaba tenuemente de plata la cresta del oleaje. El rumor de la marea al llegar a la orilla era el único sonido que se escuchaba. Quería irse, pero las piernas seguían adormecidas. Miró de nuevo hacia el frente, y entonces vio algo extraño. Una especie de fina tela amarilla que parecía caer sobre el agua. Como una aurora que se mecía por las olas. Miró con más atención. No conseguía enfocar una imagen nítida. Se restregó los ojos, y miró de nuevo, intrigado. Pero la visión continuaba siendo difusa. Tenía que descubrir qué era aquello...
Corrió hacia el viejo muelle de madera. Allí se subió a uno de los botes, y comenzó a remar. A medida que se acercaba sentía más calor. El aire se hacía más pesado, incluso algo asfixiante. El manto amarillo fue disipándose, dejando ver un punto de luz que se movía arriba y abajo, arriba y abajo. Continuó remando, cada vez más cansado. Pero no podía parar. El punto se fue transformando en una gran esfera, de la cual salían despedidos rayos en todas las direcciones. Una nube de partículas azuladas se desprendía de su superficie y volaba por el aire de forma caprichosa. El agua que la rodeaba hervía en millones de burbujas. El niño contemplaba asombrado aquel cuerpo de llamas, luces y gas. Acababa de encontrar su estrella perdida. Los ojos, completamente abiertos, se humedecían a causa de la emoción. Una lágrima resbaló por su mejilla, cayendo muy despacio hacia el océano.
Cuando su pequeña lágrima tocó la superficie del agua, la estrella comenzó a deshacerse como hielo derretido. Los restos del astro se hundieron en el mar, fragmentándose en diminutos polvos dorados, que comenzaron a parpadear en su caída. Según descendían, las diminutas motas adoptaron múltiples formas corpóreas, transformándose mágicamente en peces, calamares, medusas, caballitos de mar, rayas... y otros extraños seres de cuerpos fluorescentes, que iluminaban el fondo marino a su paso. Los últimos polvos dorados tocaron suelo, y allí se convirtieron en coloridos bosques de corales, en algas de innumerables especies distintas, en formaciones de perladas anémonas... El niño observaba fascinado el espectáculo. Era consciente de que acababa de ser el único y afortunado testigo del nacimiento de la vida marina, creada del fuego centelleante caído del cielo. Las criaturas extraterrestres pobladoras de los mares pululaban unos metros por debajo de él. Mientras, en su bote, el niño soñaba con hacer el viaje inverso, desde la Tierra hacia las estrellas, para conocer el mundo que siempre había admirado con infantil devoción.
* * *
Víctor M. Rivilla
Doctor en Astrofísica
Marie Sklodowska-Curie Fellow; Osservatorio Astrofisico di Arcetri, INAF-OAA
Mi interés por la Biogeografía nació cuando estaba realizando mi Tesis Doctoral en el Museo Nacional de Ciencias Naturales en Madrid. Estudiaba entonces un grupo de escarabajos "sanjuaneros", algunas de cuyas especies eran plaga de los olivos en Andalucía.
Las hembras de estas especies eran ápteras (sin alas) y los machos vivían apenas uno o dos días (lo suficiente para reproducirse); las larvas ("gusanos blancos") eran los responsables de los daños en la agricultura, vivían tres años bajo tierra y se alimentaban de las raíces del olivo. Lo extraordinario era que este grupo de escarabajos, con escasa movilidad y corta vida adulta, había sido capaz de extenderse por todo el sur de la Península Ibérica, y sus parientes habían colonizado áreas tan alejadas como el Cáucaso o islas mediterráneas como Sicilia o Creta. ¿Cómo llegaron hasta allí? ¿Cuándo colonizaron estos escarabajos la Península Ibérica: recientemente o hace millones de años? La Biogeografía ("bio"=vida, "geografía"=descripción de la Tierra) es la ciencia que estudia dónde y cómo se distribuye la diversidad biológica en nuestro planeta y también el por qué, los mecanismos o procesos responsables. Por ejemplo, las regiones tropicales próximas al Ecuador albergan un mayor número de especies en comparación con las regiones templadas o las polares: ¿se debe esto a diferencias en el clima o a que la mayoría de las especies se originaron en esas regiones tropicales y sólo recientemente han colonizado regiones templadas y polares? Otro puzle biogeográfico: las aves ratites (superorden Palaeognathae), a las que pertenecen el avestruz, el casuario, o el ñandú, carecen de la capacidad de volar y sin embargo ocupan casi todos los continentes del Hemisferio Sur – Nueva Zelanda, Australia, Sudamérica, África, y Nueva Guinea (Fig. 1a). ¿Cómo cruzaron el Mar de Tasmania o el Océano Pacífico estas aves? ¿Acaso podían volar sus ancestros y luego perdieron esta capacidad como sucede con muchas especies que habitan islas oceánicas?

Fig. 1. Biogeografía de las aves ratites (avestruz, causario, ñandú, etc), mostrando su distribución actual en los continentes del Hemisferio Sur (a) y la posición de estos continentes hace 150 millones de años (b).
¿O utilizaron "puentes de tierra" ahora sumergidos para cruzar entre continentes? Lo que resulta más interesante de la Biogeografía es que la respuesta implica a menudo encontrar evidencias en distintas ciencias, como la geología, la ecología, la biología molecular, o la paleontología.
Un poco de historia
Cuando Isaac Newton afirmó que "se había subido a los hombros de gigantes" para crear su revolucionaria Teoría de la Gravitación Universal, se refería a que se había basado en el conocimiento acumulado durante siglos por otros grandes matemáticos y pensadores. Esta verdad se puede aplicar a la Biogeografía, que nació como ciencia en la Era de la Exploración (siglos XVIII y XIX) y se alimentó de datos acumulados por científicos de la talla de Alexander von Humboldt, el gran viajero, o Charles Darwin y Alfred Wallace, los "padres" de la Teoría de la Evolución por Selección Natural, pero también de los grandes descubrimientos técnicos del último siglo, como el sonar. De hecho, la historia de la Biogeografía es la historia de pequeños grandes pasos. Empecemos desde el principio...Cuando el científico sueco Carlos Linneo (s. XVIII), el inventor de nuestro sistema para nombrar las especies con dos nombres (p. e. "Homo sapiens"), se encontró con el dilema de explicar cómo era posible si las especies eran el producto de la creación divina, y por tanto inmutables, fueran tan diferentes, se le ocurrió la idea de que todos los animales y plantas se originaron en la "Montaña Paraíso", en la que habitaban diferentes altitudes, las cimas y laderas. Después del Diluvio Universal, estas especies se habrían dispersado por la superficie terrestre, colonizando aquellas regiones donde el clima se asemejaba al original, es decir, las especies de cima colonizarían las regiones polares de tundra, y aquellas de ladera, las llanuras y zonas bajas. La idea de que cada especie se origina en un área "ancestral" y luego migra para colonizar otras regiones fue adoptada por los "evolucionistas" del siglo XIX con una pequeña diferencia. Darwin y Wallace proponían que la distribución actual de los organismos es el resultado de una evolución en el espacio y a lo largo del tiempo, es decir, las especies no son inmutables como pensaba Linneo, si no que pueden cambiar y dar lugar a otras especies en su adaptación a un nuevo hábitat ("descendencia con modificación"). De esta forma, la Teoría de la Evolución por Selección Natural proporcionó el "motor biológico" a la Biogeografía: especies en distintos continentes podían compartir un ancestro común. El motor "geológico" tardaría, en cambio, casi dos siglos en descubrirse.
Darwin y sus coetáneos pensaban que el tamaño y la posición de los continentes no habían cambiado a lo largo del tiempo geológico. Sin embargo, cada vez un mayor número de evidencias señalaban lo contrario: por ejemplo, el encaje como un puzle entre los márgenes continentales de África y Sudamérica, o la correspondencia entre cadenas montañosas ahora sumergidas a ambos lados del Atlántico. La Teoría de la Tectónica de Placas, desarrollada a mediados del siglo XX, cambió esta idea: se descubrió que la superficie terrestre está dividida en placas tectónicas, la litosfera, que se deslizan sobre la capa fluida del manto, la astenosfera, propulsadas por las corrientes de convección. Donde dos placas colisionan, se origina un cadena montañosa; en el punto en que se separan se forma un nuevo océano. Curiosamente, en este descubrimiento tuvo una gran importancia el uso del sonar durante la segunda guerra mundial: el geólogo Harry Hess, entonces tripulante de un submarino, descubrió en medio del océano abisal las dorsales o "grietas" oceánicas donde se forma el nuevo océano. Las consecuencias para la biogeografía fueron enormes.

Fig. 2. Árbol filogenético de las ratites mostrando su grado de parentesco, basado en (a) rasgos morfológicos y (b) diferencias en su ADN.
Por primera vez, el biogeógrafo disponía de dos tipos de mecanismos que permitían explicar las distribuciones "disyuntas": dispersión activa de las especies o transporte pasivo sobre los continentes en movimiento; estos actuarían como un "Arca de Noé", llevando consigo a las especies, o como un "barco vikingo funerario" en el caso de organismos extintos o fósiles. Para las ratites, su distribución en los continentes del Hemisferio Sur separados por océanos, podría explicarse porque estos formaban parte hace más de cien millones de años del antiguo supercontinente de Gondwana (Fig. 1b): el ancestro del grupo habitaba ese continente y a medida que éste se fragmentó por tectónica de placas, sus descendientes habrían quedado aislados en distintas regiones. De hecho como veremos (Fig. 2a), las primeras filogenias apoyaron esta explicación.
La revolución molecular y el registro fósil: "rocks and clocks"
¿Y cómo es el trabajo de un biogeógrafo? Pues comienza reconstruyendo la historia evolutiva del grupo que se quiere estudiar, es decir, el árbol genealógico (filogenia) que establece el grado de parentesco entre las especies: ¿cuáles comparten un ancestro común?, ¿cuáles están más alejadas evolutivamente? Esto se complementa con información sobre la distribución actual de las especies para poder así reconstruir su evolución en el espacio y a lo largo del tiempo: ¿qué especies se originaron en la misma región?, ¿cuáles son el resultado de la colonización de una nueva región geográfica? Durante décadas, la reconstrucción de árboles filogenéticos se basó en la identificación de similitudes morfológicas entre las especies. Sin embargo, una misma estructura puede tener un origen distinto: por ejemplo, las aletas de tiburones y ballenas realizan una misma función pero evolucionaron de forma independiente como adaptación al medio acuático: esto se conoce como convergencia evolutiva. En las plantas, esto es muy frecuente porque debido a su dependencia con el medio físico, adaptaciones similares pueden encontrarse en especies no emparentadas, por lo que los rasgos morfológicos proporcionan poca información. Para solucionar esto, las filogenias modernas suelen basarse en el código genético de las especies. Si la mayoría de las mutaciones que se acumulan en el ADN son de tipo neutral y no confieren ventaja selectiva alguna, cuánto más tiempo haya transcurrido desde la separación de dos especies, mayor número de diferencias esperamos encontrar entre sus secuencias de ADN. Esta idea es la base de la hipótesis del "reloj molecular". Calibrando estas diferencias con el registro fósil, es posible obtener estimas del tiempo de divergencia entre dos especies, y distinguir si su distribución disyunta es debida a dispersión reciente o a la tectónica de placas. La aparición del reloj molecular a mediados del siglo XX supuso una verdadera revolución en biogeografía. Cuando empecé mi licenciatura, se pensaba que los moas - esas aves ratites gigantes que habitaban Nueva Zelanda y fueron exterminadas en el siglo XV por los maoríes - y los pequeños kiwis de Nueva Zelanda eran especies hermanas que habrían divergido de un ancestro común (Fig. 2a). Sin embargo, la reconstrucción de una nueva filogenia con ADN fósil de moas reveló que esto no era así, y que los kiwis estaban más cercanos al "ave elefante" de Madagascar, una especie extinta de ratite y el ave más grande que nunca ha existido (Fig. 2b). Es más, el reloj molecular mostró que los kiwis habrían colonizado Nueva Zelanda hace 60 millones de años, cuando este continente se había separado ya del supercontinente de Gondwana. ¿Cómo lograron estas aves no voladoras atravesar el Mar de Tasmania? Aquí interviene la paleontología – el estudio del registro fósil – que en los últimos años ha cobrado gran importancia en biogeografía. Los fósiles pueden proporcionar evidencias donde los datos moleculares o la distribución actual no pueden. Por ejemplo, el registro fósil nos dice que las ratites estaban presentes en Europa, y que hasta hace quince millones de años habitaban la Península Antártica (Fig. 1a). Dado que la tectónica de placas es un proceso gradual, es posible que después de la separación de Nueva Zelanda de Gondwana, existieran conexiones en forma de islas con la Antártida que habrían permitido a los pequeños kiwi colonizar Nueva Zelanda. ¡De todas formas, la filogenia de las ratites está lejos de ser resuelta! Nuevos datos moleculares procedentes del genoma – la totalidad del material genético que posee un organismo – pueden cambiar la filogenia mostrada en la Fig. 2b. Otro ejemplo de cómo el registro fósil puede modificar nuestra visión biogeográfíca es Nueva Zelanda. La flora de este continente, rica en endemismos, se ha considerado tradicionalmente como un relicto de la antigua flora de Gondwana, que quedó aislada cuando Nueva Zelanda se separó de este supercontinente hace 80 millones de años. Esta visión de Nueva Zelanda como el "Mundo Perdido", que conserva especies endémicas que datan de los tiempos de los dinosaurios ("el continente donde el tiempo se detuvo") se ha visto cuestionada por el registro fósil, que muestra que la flora neozelandesa del período cretácico es muy distinta a la actual y que las especies de plantas presentes ahora en Nueva Zelanda tienen sus parientes más próximos en Australia. Esto es porque cuando se abrió el Estrecho de Drake entre Sudamérica y la Antártida hace 32 millones de años, se formó la Corriente Circumpolar Antártica, que mueve aguas y vientos en el sentido de las agujas del reloj, de oeste a este alrededor de la Antártida. Semillas y pequeños animales son arrastrados regularmente por estos vientos desde Australia a Nueva Zelanda, lo que explicaría la semejanza entre las floras de estos dos continentes. Es más, de acuerdo con las reconstrucciones tectónicas, cerca del 80% de Nueva Zelanda se hundió bajo el océano hace 30 millones de años. La hipótesis actual es que la flora "gondwánica" de Nueva Zelanda desapareció durante esta transgresión marina, y las especies actuales son descendientes de otras que se dispersaron desde Australia. Esta hipótesis está apoyada por el reloj molecular, que sugiere un origen reciente para las especies neozelandesas.
El futuro: integración, integración, integración... y modelos matemáticos
La biogeografía es una ciencia no experimental: no podemos ver a la evolución en marcha porque típicamente conlleva tiempos que superan la longevidad humana, pero sí podemos deducir cómo actúa basándonos en la señal que deja en el registro fósil y las moléculas de ADN. El problema es que a medida que nos movemos atrás en el tiempo, cientos de millones de años, incluso esta evidencia acaba desapareciendo: el registro fósil se hace más escaso, eliminado por la erosión en los continentes, y los cambios en el código de ADN se hacen tantos y tan repetidos que resulta imposible reconstruir su secuencia con fiabilidad. Es por eso que los "buenos" biogeógrafos necesitan ser "filtradores" y "sintetizadores", integrando múltiples tipos de evidencia: geológica, molecular, paleontológica, climática, para poder reconstruir el pasado. En nuestra ayuda viene la revolución informática: la posibilidad de contar con grandes bases de datos geográficos procedentes de satélites, pero también de modelos matemáticos, a veces complejos, para poder integrar toda la información. A pesar de todo, la biogeografía sigue siendo una ciencia bastante "especulativa": las posibilidades parecen infinitas y ¡por eso me gusta!
Isabel Sanmartín Bastida
Doctora en Biología
Departamento de Biodiversidad y Conservación
Real Jardín Botánico, CSIC
Como muchas niñas en su momento quise ser Bailarina, Cantante, Enfermera y, durante muchos años, Médico. Desde que tengo uso de razón se me dieron mejor las asignaturas de ciencias (Mates, Física, Química y Biología) y ya en el instituto al conocer la biografía de Marie Curie soñé idílicamente ser como ella.

Fig. 1. Y yo quiero ser…Bióloga Molecular!!!
Me gustaba mucho la química, me fascinaban los laboratorios y en aquel (hoy muy lejano) entonces, comenzaba la revolución científica y tecnológica que haría familiares los términos de Biología Molecular e Ingeniería Genética. Fue entonces, entrando en Bachillerato, que decidí que iba a estudiar para ser investigadora en los nuevos campos que se abrían con esas nuevas herramientas en el campo de la Biomedicina. Me enamoré del descubrimiento de la doble hélice, el código genético, el dogma central de la biología y de todas las esperanzas que se gestaban en el conocimiento de estas bases moleculares y el diagnóstico y la cura de muchas enfermedades hereditarias. Ahí surgió un dilema, ¿Qué carrera universitaria debía cursar para dedicarme a estos estudios? Con todo el estrés que lleva el último año de bachillerato, en el poco tiempo que me quedaba libre, intentaba averiguar qué debía estudiar: ¿Biología?, ¿Bioquímica?, ¿Medicina?, ¿Química? (en aquel entonces no existían carreras como la Ingeniería Genética y otras de nueva generación…). No era tarea fácil, de todas me gustaba algo y todas me daban miedo, me quedaban enormes, me parecía que el enfoque de la Medicina era un perfil formativo muy clínico y yo quería hacer investigación en un laboratorio sacado del mejor libro de ciencia ficción; Química me parecía que se alejaba mucho del área de la biomedicina, hasta que finalmente tomé la decisión de estudiar Biología y esa decisión, aún hoy me hace muy, muy feliz. Sé que uno de los mayores objetivos de este libro es motivar a chicas y chicos, adolescentes y jóvenes a hacer investigación e intentaré hacerlo. Aunque pueda parecer muy visceral, he de confesarles que una vida dedicada a la investigación es una vida de grandes sacrificios y aún mayor dedicación pero que el descubrimiento y ser capaz de encontrar explicaciones científicas a aquello que nos preguntamos, genera una satisfacción tan enorme que compensa con creces todos los sacrificios personales y el tiempo que invertimos en generarlos y si además, logramos con ello abrir nuevas rutas de terapias y diagnósticos que alivien a pacientes y familiares pues ya esa satisfacción es inconmensurable.
¿Qué es la Biología Molecular?
La Biología Molecular es una disciplina científica que tiene como objetivo el estudio de los procesos que se desarrollan en los seres vivos desde un punto de vista molecular. Dentro del Proyecto Genoma Humano se define como: El estudio de la estructura, función y composición de moléculas biológicamente importantes.

Fig. 2. Esquema sobre la relación entre la genética, la bioquímica y la biología molecular.
Está relacionada con otros campos de la Biología y la Química, particularmente con la Genética y la Bioquímica. La biología molecular concierne principalmente a la comprensión de las interacciones de los diferentes sistemas celulares, lo que incluye muchísimas relaciones, entre ellas las del ADN con el ARN, la síntesis de proteínas, el metabolismo en general, y estudiar y comprender cómo todas esas interacciones son reguladas para conseguir un correcto funcionamiento de la célula y en última instancia, el organismo.
Al estudiar el comportamiento biológico de las moléculas que componen las células vivas, la biología molecular interacciona con otras ciencias que abordan temas similares: así, p. ej., junto a la genética estudia la estructura y funcionamiento de los genes y su regulación (inducción y represión). Por otro lado, en común con la bioquímica estudia las rutas metabólicas, la composición y mecanismo de acción de las enzimas, los tipos de catálisis enzimática, etc. También se relaciona con la filogenética al estudiar la composición detallada de determinadas moléculas en las distintas especies de seres vivos, aportando valiosos datos para el conocimiento de los procesos evolutivos.
Por consiguiente, definir barreras entre las diferentes disciplinas de investigación es muy artificial y complicado. A día de hoy, la inmensa mayoría de grupos de investigación, tanto los que se dedican a la investigación más básica como los de perfiles de investigación más aplicada, se conforman de diversos perfiles formativos que trabajan en un proyecto común y en el que cada cual aporta todo su ingenio y conocimiento para responder las preguntas más elementales de cualquier proceso investigativo, ¿Por qué?, ¿Cómo? y ¿Para qué?
¿Con qué herramientas contamos cuándo hablamos de Ingeniería Genética, Biología Molecular o Medicina Personalizada?
El desarrollo tecnológico de las dos últimas décadas ha proporcionado un salto cuantitativo y cualitativo en la forma de abordar la investigación de procesos biológicos. La Biología y la Medicina han experimentado un proceso de "molecularización" que trata de entender las bases moleculares que sustentan todos los procesos biológicos. Proyectos tan revolucionarios como el Proyecto del Genoma Humano han generado que la biología molecular no se circunscriba únicamente a un área de investigación biomédica, sino que abre nuevos campos de actuación directamente en la clínica en forma de sistemas diagnósticos, pronósticos y terapéuticos basados en herramientas moleculares. Es por ello que se hace imprescindible que las nuevas generaciones, al igual que se han ido familiarizando con la era digital en todo ámbito de la vida diaria, vengan también familiarizadas con términos como "Medicina Personalizada" que no es más que el empleo de técnicas de biología molecular en la rutina médica diaria.
Partir de una sola célula o de un corte de una micra de un tejido humano y ser capaces de extraer toda la información genética, epigenética y metabólica del mismo parece sacado de una película americana del futuro, pero hoy es posible hacer todo esto y más aplicando técnicas que, en su gran mayoría, son sólo copias ingeniosamente adaptadas de mecanismos que existen en la gran diversidad de nuestra naturaleza.
La técnica más elemental de la ingeniería genética (que consiste fundamentalmente en extraer ADN de un organismo y transferirlo y expresarlo en otro) consiste en amplificar genes empleando la "reacción en cadena de la polimerasa" o sus ya muy reconocidas siglas en inglés "PCR", logro que supuso la concesión del premio Nobel de Química en 1993 a Kary Mullis consiste en copiar los mecanismos que emplean los organismos vivos para replicar el material genético incluyendo todo lo aprendido de aquellos organismos que viven en condiciones extremas, pues la enzima que se emplea hoy en día para copiar el ADN en cada ciclo de amplificación proviene de un organismo que es capaz de vivir a temperaturas comprendidas entre 50 y 80 °C, gracias a que sus enzimas resisten tales condiciones. Normalmente, a esas temperaturas las proteínas constitutivas de la mayoría de los seres vivos se desnaturalizan y no vuelven a ser funcionales.

Fig. 4. Representación esquemática de la tecnología CRISPR. (Modificado de NatRevMicrobiol. 2013 Oct;11(10):675-87. doi:10.1038/nrmicro3096.Epub 2013 Aug 27)
Otro ejemplo del empleo de tecnología que muy recientemente se ha implementado en nuestros laboratorios y que ha revolucionado metodológicamente la investigación biomédica es la tecnología del CRISPR. Esta tecnología es una herramienta molecular utilizada para "editar" el genoma de cualquier célula, incluidas., por supuesto, las células humanas. Sería algo así como unas tijeras moleculares que son capaces de cortar cualquier molécula de ADN, haciéndolo además de una manera muy precisa y totalmente controlada. Esa capacidad de cortar el ADN es lo que permite modificar su secuencia, eliminando o insertando nuevo ADN. Esta tecnología que ya ha comenzado a dar sus frutos en nuevas investigaciones tiene su origen en el sistema de defensa, ante infecciones virales, de una bacteria llamada Streptococcus pyogenes. Estas bacterias tienen enzimas capaces de diferenciar el ADN de la bacteria y el del virus y, una vez hecha la distinción, destruyen al material genético del virus. Aún no hay terapias disponibles empleando esta tecnología, pero es sólo cuestión de tiempo pues desde Octubre de 2016 ya hay aprobados varios ensayos clínicos que utilizan esta tecnología para "corregir" células de pacientes. Sin embargo, si ha sido empleada exitosamente en la generación de modelos de animales transgénicos así como en modelos celulares.
¿Sabías que…?
- Toda la raza humana, independientemente de color de la piel, aspecto físico u origen geográfico somos 99,9% idénticos? De hecho, los seres humanos y los chimpancés (nuestros vecinos más cercanos en el árbol de la vida) tenemos más de un 98% de similitud en nuestras moléculas de ADN.
- De los 8 premios Nobel otorgados a ciudadanos españoles, dos han sido en Medicina? En 1906 al médico Santiago Ramón y Cajal por sus trabajos y aportaciones a la neurociencia y en 1959 al biólogo molecular Severo Ochoa de Albornoz por sus descubrimientos sobre el mecanismo de la síntesis biológica del ácido ribonucleico (ARN) y del ácido desoxirribonucleico (ADN).
- El investigador español Francis Mojica fue el descubridor del mecanismo CRISPR/Cas cuando a principios de los 90 estudiaba unas bacterias que viven en las salinas de Santa Pola (Alicante) llamadas Haloferax mediterranei y descubrió que eran capaces de incorporar a su propio ADN el de otras bacterias o virus que las atacan para inmunizarse contra ellos? Por este descubrimiento ha sido postulado para el premio Nobel en el año 2017.
- Mediante el empleo de la tecnología CRISPR, científicos han deleccionado el gen responsable de que los champiñones se pongan marrones al contacto con el aire (gen que codifica para la enzima Polifenol Oxidasa). Este procedimiento no deja huella en los organismos generados, por lo que no se consideran transgénicos.
Marta Dueñas Porto
Doctor en Ciencias Biológicas
Investigadora Titulada Superior en la Unidad de Oncología Molecular (CIEMAT), Madrid, España
¿Por qué ser científica? Gran pregunta, que aunque parezca fácil de responder no lo es. ¿Por qué lo soy o estoy en proceso de serlo? ¿Ser científico se nace o se hace? Pues como todo en esta vida, un poco de todo, una de cal y otra de arena, un poco de dulce y otro de salado.
Todos nacemos "científicos", no científicos como tal, de estos que descubren las ondas gravitacionales o fenómenos como el CRISPR, que ayudan a la edición génica y luego se quedan sin el Nobel. No, nacemos curiosos, exploradores de las pequeñas cosas, del mundo que nos rodea.
¿Quién no de pequeño ha intentado meter los dedos en un enchufe? ¿Ha observado cómo se comportan las hormigas? ¿Ha jugado a hacer mejunjes con el vino, café, coca-cola de los familiares en alguna comida o ha tenido la época del "por qué"? Eso es la esencia de un científico a grandes rasgos, "el explorar lo inexplorable" como dirían en la película de "UP". Todos nacemos con esa curiosidad innata, si no, no hubiéramos evolucionado a lo largo del tiempo. Sin ella, no hubiéramos llegado a vivir como vivimos ahora, con todas las comodidades del mundo y seguiríamos en las cavernas hablando el "unka unka".
A medida que vamos creciendo, que vamos descubriendo el mundo, ya sea por la sociedad o el ambiente en el que nos movemos, nos vamos especializando y centrando en lo que queremos ser. Nos decantamos por lo que realmente nos gusta y somos buenos en eso, y parece que esa curiosidad y esas ganas de experimentar se van perdiendo. Sin embargo, todos llevamos a un científico dentro, ya sea tanto de ciencias como de letras. Si uno vive con pasión lo que le gusta y tiene ganas de aprender, siempre mantendrá a ese niño explorador y curioso dentro, con ganas de seguir descubriendo el mundo.
No sólo se investiga en ciencia y medicina, se investiga en derecho, en psicología, en economía, en informática, en todo lo inimaginable. Por eso, no debemos obligar nunca a los más pequeños a estudiar una carrera que no les guste. Nunca hay que romper la ilusión por la curiosidad. Da igual que estudien física o filología, porque si realmente sienten pasión por lo que hacen, lo harán bien y lo transmitirán tanto a sus compañeros de trabajo como a sus familiares y amigos, o a las personas para las que trabajen.
Vale, sí, todo esto queda demasiado bonito para ser real, porque entonces si no, no habría tanta gente quemada y frustrada por su trabajo. ¿Entonces por qué hay gente que no es feliz en lo que hace? En realidad parte de culpa es por esta sociedad en la que vivimos. Nuestra sociedad se basa en ganar dinero y engañar a los demás para ver quién llega a lo más alto, en producir y vender sin valorar el trabajo que hay detrás. Se basa en la competitividad y en la lucha de unos contra otros. Se pierde esa esencia de las ganas de aprender, de explorar, de colaborar. Se pierde todo.
Yo, como Bióloga con Máster en Biomedicina Molecular y casi terminando la tesis doctoral, que a uno parece que se le llena la boca al decirlo, podría seguir acumulando títulos eternamente, y aún así, seguir frustrada o quemada. Los títulos dan igual si no se consiguen los resultados que se quieren para publicar o se obtienen, pero otro grupo "los pisa". El trabajo y el esfuerzo no parecen ser ni valorados ni recompensados y no se consigue el puesto que se quiere. Dicen que la ciencia es un sacrificio.
La gente que hacemos la tesis, y sobre todo, en cosas relacionadas con laboratorio, nos dicen que el laboratorio está abierto 365 días al año, todos los días de la semana (incluidos fines de semana) durante las 24h del día. ¡Vaya! Pues sí que parece un sacrificio, sí. Pero ¿por qué tiene que serlo? ¿En qué punto cuando crecemos y entramos a esta jungla del mundo laboral, el trabajo se convierte de ser pasión a perdición y sacrificio? ¿Por qué perdemos esa esencia? A mí me gusta el tema en el que trabajo, me gusta porque estudio la vida. En concreto, estudio el corazón e intento indagar qué pasa cuando se genera un infarto. Intento responder al por qué las proteínas que investigo, parecen proteger frente al daño en el corazón. Estudio a nivel molecular lo que pasa en uno de los primeros niveles más básicos, pero que es más complejo de lo que parece. Este nivel es la base, la base de la vida, unas moléculas que se unen e interaccionan, que usan la química y la física para dar vías de comunicación entre ellas. Esto no se queda ahí, esto genera sistemas más complejos que dan lugar a algo con capacidad de reproducirse, de alimentarse, de generar otras cosas más grandes, de dar tejidos, órganos e individuos. Estos individuos hacen todo esto a una escala mayor, se relacionan con otros y generan manadas y/o sociedades dentro de un ecosistema, dentro de un mundo en el que vivimos y convivimos todos. Todo está relacionado, desde el virus (vivo o inerte, sin entrar en disputa) hasta una colonia de bacterias, desde estas hasta seres pluricelulares y desde estos a sociedades complejas y ecosistemas. Todos necesitamos de todos.
Volviendo a la pregunta del principio (sí, ya lo sé, me extiendo demasiado), realmente nunca pensé en estudiar Biología tal cual. Cuando eres pequeño y te preguntan qué quieres ser de mayor, muchos dicen médico, bombero, policía, pero yo realmente no lo sabía. Yo sólo sabía que me gustaba mirar cosas diminutas con el microscopio que me regalaron mis padres, hacer mejunjes después de las comidas u observar a los bichos cuando estaba sentada en algún parque, pero no sabía que existía la carrera de Biología. Según fui creciendo y aprendiendo más cosas, vi que me encantaban las "ciencias naturales", más cuando pudimos bajar al "laboratorio" a hacer algunas pruebas con células vegetales o examinar la anatomía de un riñón o una cabeza de cordero. Cuando uno llega a Bachillerato, todo el mundo te empieza a agobiar con la nota, qué quieres estudiar, a qué Universidad vas a ir, que piénsatelo bien. Sinceramente, yo acabé hecha más lío, ya no sabía si quería estudiar química, farmacia, medicina, ambientales o biología. "Biología" que palabra tan amplia y nadie antes me había hablado de ella como para estudiar una carrera. Tras pensar y pensar, puse Biología en mi solicitud. Tras 5 cortos años, acabé la carrera y la volvería a repetir una y otra vez. Nunca pensé que esa gran desconocida, esa palabra que parece que lo tiene todo, pero que a la vez no cuenta nada, iba a ser mi favorita. Biología, fueron 5 años en los que disfruté estudiando, pensando, investigando, haciendo buenos amigos, sintiendo que podía saberlo todo, pero que a la vez no sabía nada. Se acabó y decidí que quería saber más. Hice un máster en Biomedicina molecular y luego me embarqué en la aventura de la Tesis. Tuve la oportunidad de poder seguir curioseando, de seguir aprendiendo, de realmente investigar. Puedo ver cómo se comportan unas células cuando les pongo un tratamiento, ver cómo esas células se comportan en un tejido y cómo éste se comporta dentro de un organismo y reacciona. Veo como todo está relacionado. Todo forma parte de un todo mayor, forma parte de la vida, de lo que de pequeña no sabía cómo expresar qué quería ser. Ahora lo sé un poco más, quiero ser bióloga, la persona que estudia la vida, desde las moléculas al organismo en sí.
Independientemente de a qué me dedique una vez finalice la tesis, y se me llene la boca diciendo que soy Doctora en Biomedicina Molecular, que suena bien la verdad, estoy orgullosa y no me arrepiento para nada de haber estudiado la carrera qué he estudiado. A pesar de que dedicarse a la ciencia, y más en España, es difícil, me gusta mantener esa ilusión y esa curiosidad por experimentar, por saber más, por descubrir el mundo. No quiero el premio Nobel ni ser una súper científica, quiero que no me quiten mis ganas de seguir siendo Bióloga Molecular.
Patricia Sánchez Pérez
Estudiante de Doctorado en Biomedicina
Universidad Autónoma de Madrid
Yo no voy a contaros que desde que tengo uso de razón sé que sería Bióloga Marina, os mentiría. No voy a contaros que para ser científicos tenéis que tener una ferviente vocación, porque, no solo los que saben lo que quieren exactamente consiguen llegar a la meta, y es que hay muchas maneras de ver esa "meta". Si vosotros, al igual que yo con vuestra edad, aún no sabéis lo que queréis ser de mayor… tranquilos, no hace falta que lo sepáis. Si vuestra vecina sabe que quiere ser médico, es maravilloso, seguro que conoce los pasos quedar para conseguirlo y focaliza todas sus energías en ello. Tal vez, vuestra vecina se ha planteado en algún momento qué pasa si no consigue ser médico. Hay veces que nos tomamos nuestros objetivos de vida muy en serio, apostamos todo, trabajamos duro y aun así no lo conseguimos. Tranquilos, tampoco importa, porque al final, todo lo que aprendemos en nuestra vida sirve, es lo que algunos llaman, experiencia de vida. Pero eso sí, debemos esforzarnos al máximo en cada una de nuestras batallas, dar nuestro mejor yo, y ser conscientes de que somos los responsables de nuestros actos. Quiero contaros mi historia, ya que, para mí, la meta es todo el recorrido, es decir, que no hay meta, que lo genial es el camino que se construye con cada decisión que vamos tomando. Yo he ido creando mi rumbo, con cada elección que he ido tomando. Dejo en este capítulo las palabras clave que me han servido para tomar decisiones y me han traído hasta aquí, hasta ser Bióloga Marina, porque tal vez a vosotros también os ayuden.
Con vuestra edad no podía entender por qué mis amigos tenían tan claro a qué querían dedicarse y yo no. Artes, matemáticas, deportes, veterinaria, astrología… cada vez que encontraba algo que me asombrara, yo quería ser eso de mayor. Al final entendí que lo que me gustaba era DESCUBRIR cosas nuevas y alucinantes. En un momento de mi adolescencia recuerdo haber escuchado a algún adulto diciendo, "sabemos que el mundo está mal, pero vosotros podréis arreglarlo, sois la nueva generación y venís muy preparados". Esto nos quedaba, y nos queda, grande a todos, aun así, siempre he creído que ese motivo no es suficiente para mirar a otro lado. Yo quería APORTAR mi granito para mejorar las cosas. En mi caso, sentía más sensibilidad por la naturaleza, que no tenía culpa alguna de las barbaridades que le hacíamos. Además, sus secretos despertaban en mí una gran CURIOSIDAD y no dejaba de sorprenderme con cada cosa que aprendía sobre ella.
Cuando terminé bachillerato, mis padres, que no habían tenido la oportunidad de estudiar, me hicieron el mejor regalo. Me dijeron que podía ir a la Universidad y que eligiera la carrera que me diera FELICIDAD, no dinero ni trabajo, solo lo que me hiciera feliz en los siguientes 5 años. En ese momento, seguía sin saber lo que quería ser exactamente, pero tenía que decidir. Junté todo lo que conocía de mi misma y todo lo que me producía INTERÉS, para tomar la primera elección importante en mi vida. Serían 5 años aprendiendo la ciencia de la vida, elegí Biología.
Cada tarde, al llegar a la casa que compartía con mis amigas en Salamanca, les contaba todo lo que había aprendido. Como cuando me explicaron cómo pasa un trozo de carne que estás masticando, a ser energía para mover un musculo o por qué no se estropean los encurtidos, cómo es la estructura de un nucleótido, cómo madura una naranja, cómo respira un cangrejo, porqué huele a "tierra mojada" cuando llueve, qué hace un foraminífero como tú en un sitio como este…Cuantas más respuestas tenía, más preguntas surgían. Descubrí que, cuando se trata de cosas que te motivan, no cuesta madrugar para hacer cola en la Biblioteca. En un abrir y cerrar de ojos, yo, que nunca había sido una buena estudiante, que cometía millones de faltas de ortografía y que era incapaz de recordar un nombre o un año, estaba a punto de licenciarme con un buen expediente y pudiendo reconocer 589 especies vegetales y 462 anímales con sus nombres en latín, familias, órdenes y características más relevantes. Y claro que me costó, claro que pasé horas delante de los apuntes, del herbario o del ordenador, pero siempre con una sonrisa. Y es que, cuando te enseñan cosas que te dejan con la boca abierta, cuando puedes resolver tus dudas usando conceptos de diferentes campos, es muy fácil aprender.
Cuando terminé la carrera, seguía sin tener claro en qué quería trabajar, pero prometí no estudiar más y no volver a pisar ninguna universidad. Tres meses más tarde, se coló en mi email un anuncio de un Máster de Bilogía Marina en la Universidad de Vigo. En ese momento, afloraron todas esas palabras: curiosidad, interés, felicidad, aportar, descubrir. El mar me había dejado intrigada desde aquella práctica de vertebrados en la que nuestro profesor nos plantó en Menorca con un traje de buzo y una botella, no lo supe hasta más tarde, pero ahí me enamoré del mar. Esta vez en Castilla y sin saber nada del océano, decidí que tenía que aprender los secretos del gigante azul y regresé a la universidad. En mi trabajo de Fin de Máster comencé a investigar de verdad, no solo con libros. Monté un experimento en la playa para analizar la descomposición de las algas que se acumulaban en la orilla. Pudimos demostrar que el aporte de nutrientes es muy importante para el funcionamiento de las playas arenosas y que es mejor no retirar las algas por mucho que los turistas se quejen. Ese fue mi primer granito de arena, ahí supe que me gustaba investigar, a pesar de eso, no estaba segura de querer seguir adelante con la carrera científica.
Entonces volvió a ocurrir, mientras trabajaba como educadora ambiental en Aulas de la Naturaleza me dio un salto el corazón cuando vi una oferta para realizar un doctorado en Biología Marina en la Universidad de Cádiz. Aquella vez me lo pensé un poquito más, pero por si acaso, eché los papeles muy rápido, para decir que no siempre hay tiempo. Sabía que era mi última oportunidad para alargar un poquito más mi vida cómo bióloga, y así poder investigar, descubrir cosas alucinantes y dejar algún granito más en el camino, ayudando a la conservación de nuestros mares. Nunca me había planteado hacer una tesis doctoral, pero quería seguir aprendiendo y podría compaginarlo con mi trabajo. Pronto tuve respuesta de la Universidad de Cádiz. ¡Me habían aceptado! Recuerdo que pensé que había hecho lo correcto porque estaba muy feliz.

Fig. 1. Un ejemplar macho de Nepinnotheresnovaezelandiae intentando entrar en un mejillón verde, Perna canaliculus, en Marsden Point, Nueva Zelanda.
Con mucha ilusión y con un director de tesis más entusiasta aún que yo, comencé un proyecto de tesis doctoral sobre el efecto de los humanos en las playas rocosas en el Instituto de Ciencias Marinas de Andalucía perteneciente al CSIC. Podría estudiar los problemas que causamos y así podría encontrar una solución para cuidar estas zonas tan importantes para la vida marina. Tras dos años compaginando trabajos, obtuve una beca gracias a las publicaciones científicas que habíamos realizado en el departamento. Esto me ha permitido tener una dedicación exclusiva en este nuevo proyecto que estudia a unos pequeños cangrejos guisante que parasitan a moluscos bivalvos como mejillones y berberechos. Reconozco que soy una afortunada por poder vivir haciendo lo que me gusta, aunque a mis 16 no supiese que era exactamente esto lo que quería. La ciencia me ha dado la oportunidad de realizar dos estancias de investigación, una en Costa Rica y otra en Nueva Zelanda, dónde me encuentro en este momento, ambas son experiencias únicas. Aún tengo que defender la Tesis Doctoral y aunque son muchas horas de preparación, lo estoy disfrutando al máximo, porque sé que en dos años acabará y puede que no pueda aportar más granitos de arena con la ciencia, sin embargo, seguiré dejándolos de otra manera.
Cómo veis no soy una bióloga marina vocacional, pero he ido eligiendo poco a poco, hasta llegar aquí. He trabajado duro pero siempre he disfrutado del trabajo que hacía. Me gustaría deciros que no tengáis miedo, que no importa si no sabéis exactamente qué queréis. Lo mejor de vuestro momento es que tenéis todo el abanico de posibilidades abierto para escoger, os irán apareciendo oportunidades, seleccionar aquellas que presintáis que os harán felices, anqué parezcan imposibles, porque siempre se aprende algo y ese algo puede que sea clave en el futuro. Sois los responsables de vuestras elecciones, haced que vuestro camino sea divertido y os haga felices, haced que vuestro camino sea la meta. Y por supuesto disfrutadlo, suerte.
Marta Pérez Miguel
Estudiante de Doctorado de Biología Marina; Instituto de Ciencias Marinas de Andalucía, CSIC
En los inicios de la biomedicina, una gran parte de los procedimientos experimentales se realizaban en animales o directamente en personas. Baste recordar los inicios de las vacunas con los ensayos de Edward Jenner, inoculando a un niño con un virus vivo (y mortal) en 1796, o los niños que viajaron en barco portando en su cuerpo la vacuna de la viruela para que el virus atenuado llegase vivo a América en 1803. Hoy en día todo esto se consideraría inaceptable y nos horrorizaría que así se siguiese haciendo. Aunque la experimentación animal sigue existiendo, por suerte hoy en los laboratorios se utilizan con frecuencia técnicas que se valen de modelos experimentales como los cultivos celulares (células animales o humanas que crecen en frascos de plástico) o directamente las llamadas técnicas "in vitro" (experimentos que se realizan dentro de un tubo de ensayo). Pero hay un paso más que todavía podemos dar: ¿y si pudiéramos prescindir de todos los modelos experimentales? Aquí es donde la biología computacional tiene mucho que decir (bueno: todavía no mucho, pero sí que lo hará en los próximos 10 años). Ahora mismo se pueden generar modelos computacionales capaces de simular a escala atómica reacciones químicas catalizadas por enzimas virales, bacterianas o humanas. Y con esta información podemos diseñar fármacos (que funcionan). Todo ello dentro de un ordenador. Como si fuese el entorno virtual de un videojuego realista hasta el mínimo detalle. Dentro de pocos años podremos simular células enteras y, quién sabe, organismos enteros: un cuerpo humano virtual donde realizar ensayos de todo tipo sin riesgo ni daño para nadie.
Pero vamos despacio. ¿Cómo llegué a dedicarme a la biología computacional? Yo nací en 1965, cuando todavía no habían aparecido ni las terminales de vídeo ni los teclados electrónicos. En la película "2001: Una odisea del espacio", estrenada en 1968, el ordenador "HAL 9000" no tenía teclado (lo introdujeron de tapadillo en la segunda parte, estrenada en 1984).

Fig. 1. Los modelos tridimensionales de las moléculas biológicas son capaces de simular movimientos reales dentro del ordenador.
De niño yo no podía soñar en convertirme en biólogo computacional: no existía tal concepto. Quería ser biólogo a secas. Recuerdo algunos veranos, con 10-11 años, en los que buceaba en el río Duero, a su paso por Covaleda, en Soria, recolectando datos en un cuaderno con lo que observaba del comportamiento de unos animalillos que me llamaban mucho la atención: las larvas de tricóptero (o gusanos de canutillo).Años más tarde comencé mis estudios de biología en la universidad, donde descubrí que lo que me gustaba era la biología molecular. Y donde decidí que quería ser investigador. Durante los años de tesis doctoral, en el departamento de la universidad, teníamos una terminal de ordenador ¡por cada planta del edificio! para compartir entre todos. Y fue en esa época, aproximadamente en 1990, cuando aparecieron los primeros PCs. Con el sueldo de tres meses de beca me compré uno de aquellos aparatos (con 20 megabytes de disco duro), con los que se podía escribir la tesis sin necesidad de usar la máquina de escribir. Y que también se podían programar: eso lo cambiaba todo. Diez años más tarde estaba ya trabajando con imágenes virtuales de proteínas y localizando mutaciones en modelos tridimensionales de moléculas biológicas que giraban en la pantalla del ordenador.
¿Cómo se trabaja hoy en un laboratorio de biología computacional?
Los laboratorios de biología computacional tienen los mismos objetivos que cualquier laboratorio de biología molecular: entender el funcionamiento de los sistemas biológicos y utilizar ese conocimiento para mejorar nuestro mundo (por ejemplo, curando enfermedades o modificando cultivos para hacerlos resistentes a la sequía). La diferencia reside en las técnicas que se utilizan: únicamente procesadores y bases de datos.

Fig. 2. Modelo tridimensional de un dímero de una proteína bacteriana (FtsZ). En color azul las cargas electrostáticas positivas. En rojo las negativas. En el hueco que hay en medio (en color verde) encajan los compuestos virtuales que inhibirán su funcionamiento, impidiendo que la bacteria prolifere.
Al entrar en un laboratorio de biología computacional lo que únicamente se ve son ordenadores y gente que se afana delante de las pantallas (y una máquina de café). Además, los ordenadores que hay en la sala no son realmente los que están trabajando: son únicamente terminales con las que conectarse a las verdaderas máquinas de cálculo, situadas en salas especialmente acondicionadas.
Y, dentro de estas máquinas, los investigadores están generando un mundo que pretende ser una imagen virtual del mundo físico. Se fabrican ácidos nucleicos y proteínas. Se les dota de movimiento gracias a complejos cálculos en los que se analizan y simulan las fuerzas que gobiernan las interacciones entre átomos dentro de las moléculas.
En este mundo virtual, las distancias se miden en millonésimas de centímetro y los átomos chocan, se atraen y se separan en escalas de tiempo de trillonésimas de segundo. Y gracias a estos movimientos de los átomos que las componen, las proteínas se agitan, giran, se unen a otras proteínas, intervienen en reacciones químicas. En esencia, se simula cómo ocurren realmente todas estas acciones en las células del universo real.
Para ello hay que comenzar estudiando los planos. Algunos investigadores trabajan con secuencias de ácidos nucleicos de increíble longitud: cientos de millones de palabras con las letras AGCT a las que hay que encontrar un sentido. Encerrados en ellas se encuentran los esquemas del universo virtual. Hay que saber interpretarlos para poder construir correctamente las proteínas. Y para interpretar también los errores que provocan alteraciones como el cáncer o los defectos congénitos responsables de las enfermedades raras.
Una parte muy interesante del trabajo es la simulación detallada de las reacciones enzimáticas que ocurren dentro de las proteínas. Queremos ser capaces de imitar en nuestro mundo virtual hasta el último detalle de los pasos que transforman un compuesto químico en otro. Y entender cómo se las apañan las proteínas para facilitar estas violentas reacciones en el interior de algo tan delicado como una célula. Este espacio tridimensional está lleno de pequeñas moléculas cargadas de energía, de átomos metálicos o de moléculas de agua que interaccionan con todos ellos e intervienen en las reacciones. Es una tarea larga que ya está dando sus frutos, por ejemplo, en la simulación de determinadas proteínas bacterianas que se utilizan como blanco en el diseño de antibióticos de nueva generación.

Fig. 3. Un compuesto virtual encajando en el hueco de la fig. 2. Este compuesto es capaz de detener la división de bacterias multiresistentes creciendo en el laboratorio. En un futuro, podrá servir para curar infecciones graves en pacientes.
Con toda esta información, los investigadores construyen, entre otros proyectos, un sistema automático de síntesis de fármacos. Para ello utilizan imágenes tridimensionales de los volúmenes de las proteínas e intentan encajar en los huecos que aparecen en su superficie millones de compuestos químicos de una forma sistemática. No solo hay que tener en cuenta que el tamaño y la forma de los compuestos sean adecuados. También hay que pensar a escala atómica: aquí las cargas electrostáticas son importantes y simularlas adecuadamente no es sencillo. Pero pese a todo se están obteniendo buenos resultados, en particular en el diseño de nuevos antimicrobianos dirigidos contra bacterias multiresistentes. Y también en el descubrimiento de posibles nuevos antitumorales.
¿Qué tengo que estudiar para ser un biólogo computacional?
En los laboratorios de biología computacional trabajan juntos expertos en muy diferentes áreas, en un ejemplo excelente de interdisciplinaridad: Físicos desarrollando métodos de simulación cada vez más exactos y más rápidos del movimiento de los átomos en moléculas biológicas; Químicos y Farmacéuticos diseñando y analizando características de metabolitos y futuros fármacos; Biólogos realizando simulaciones de macromoléculas y sus redes celulares de interacción y Médicos integrando la información molecular en nuevos métodos terapéuticos y de diagnóstico. Y, por supuesto, Informáticos manejando la cada vez más ingente cantidad de información y los procesadores cada vez más complejos y rápidos (ojo: los procesadores cuánticos están ya a la vuelta de la esquina y programarlos no es sencillo).
¿Cuál es el futuro de la biología computacional?
Es difícil saber cuál será el futuro de una ciencia. Los pasos que se dan cada año son de gigante. Pero, como comentaba al principio, el futuro a medio y largo plazo es construir una réplica exacta y funcional de una célula o un organismo real en el mundo virtual, con todos los átomos interaccionando unos con otros de la misma forma que lo hacen en el universo físico. Cuando esto se consiga, no hará falta realizar más experimentos en tubos de ensayo o en placas de Petri: bastará una buena conexión a internet para ensayar el efecto de millones de compuestos sobre una proteína, o sobre una vía metabólica, y escoger el mejor de ellos para sintetizarlo como fármaco (antitumoral, antibacteriano, antiviral,...). O para analizar el efecto de una mutación en el organismo, ensayar a continuación la mejor manera de revertirla y decidir así qué terapia génica es la más adecuada para cada paciente con una enfermedad rara.
Hoy es casi ciencia ficción; pero por poco tiempo.
Paulino Gómez-Puertas
Doctor en Bioquímica y Biología Molecular
Científico Titular CSIC. Centro de Biología Molecular "Severo Ochoa" (CBMSO, CSIC-UAM), Madrid
Qué puede llegar a ser un biólogo evolucionista: Intérprete de la información biológica
Le debo a Quintín Garrido su sugerencia de figurar como intérprete. La idea inicialmente me pareció bien y, aunque me sorprendió, se me ajustaba más ser un intérprete que un especialista acorazado de saber. Algunos sinónimos de interpretar son: descifrar, estudiar y analizar. Estas definiciones me parecían compatibles con mi trayectoria vital: dudar de lo que se sabe, como científico, para explicar como profesor.
Como todos los niños de los años 50 crecí alimentado a diario de las grandes certezas de aquellos tiempos. En los 70, la Universidad provocó que mis dudas adolescentes cristalizaran con fuerza. Íbamos pasando asignaturas y cursos, y acumulando conocimientos; pero estos eran fragmentados y deslavazados: faltaba la evolución.
De Darwin al sistema inmunitario como modelo de evolución
La coherencia entre ser vivo y sus condiciones de vida constituye una de las características más importantes de la teoría evolucionista de Darwin, posteriormente depreciada por la teoría sintética, así llamada por forzar la síntesis entre el darwinismo y la genética. La genética comienza cuando Mendel demuestra que los determinantes hereditarios (genes) se transmiten como partículas independientes de generación en generación. Mientras Mendel aborda certeramente el estudio de la herencia, analizando estadísticamente uno o dos caracteres, Darwin resalta la importancia de la selección, mantenida en el tiempo, de una constelación de variaciones mediante una fina adaptación al medio natural, no una o unas pocas muy evidentes. Darwin se centra directamente en el fenotipo: las características observables de un ser vivo considerado como un todo -la estructura física y la fisiología del individuo: picos, garras, dientes- y subraya el carácter conservador y acumulador –y no generador directo de variaciones- de la selección natural, merced a la reproducción diferencial de los individuos de una especie que presentan los fenotipos más adecuados.

Fig. 1. Puzle conformacional en el reconocimiento antigénico.
Frente al pensamiento de Darwin, incluso la visión menos reduccionista de la teoría sintética planteó posiciones inflexibles de herencia genética dura: ni los caracteres adquiridos ni las influencias ambientales se heredan. Al formalizarse el denominado "dogma central de la biología molecular"-que, al menos, tiene la virtud de establecer una relación directa y unidireccional entre genotipo (secuencia de nucleótidos del ADN) y primer nivel de fenotipo (secuencia de aminoácidos de las proteínas)- se evita, por fin, la transferencia mágica entre gen y carácter: el fenotipo tiene que ver con la secuencia de aminoácidos de cada proteína, que condiciona –pero no determina- su estructura tridimensional y su función. No conocemos genes que posean en sí propiedades intrínsecas que los diferencien de otros genes y, realmente, no hay genes "reguladores" sino genes que codifican proteínas "reguladoras", según sea su posición en las rutas celulares.
El planteamiento del origen y evolución de las proteínas me llevó a iniciar una tesis doctoral relacionada con el sistema inmunitario, donde interpreté que la discriminación entre lo propio y lo ajeno se produce sobre la base de lo común y lo diferencial de la evolución de las proteínas. Tras estudiar los receptores antigénicos, planteé sendas hipótesis:
Por una parte, que éstos procedían evolutivamente de proteínas chaperonas y, por otra, que en la evolución de las proteínas lo común son los módulos estructurales básicos, seleccionados en la etapa prebiótica; y lo diferencial la diversidad en la secuencia de aminoácidos, generada durante la evolución biológica.
Respecto al reconocimiento inmunológico propuse que los péptidos antigénicos reconocidos por los linfocitos T -lo que considero común de la estructura de las proteínas- formarían un empaquetamiento estable, en una suerte de puzle conformacional, con el sitio de unión de las proteínas de histocompatibilidad que, así, actuaría como pieza maestra (o comodín) que pudiese interaccionar con cualquier péptido del puzle. Estas interacciones remedarían la selección de péptidos y proteínas durante la etapa prebiótica.
Origen, naturaleza y evolución de la información estructural
La hipótesis del puzle conformacional nos sitúa en un escenario de la evolución proteica en dos actos:
-Una primera etapa de evolución prebiótica conformacional donde, a partir de secuencias polipeptídicas formadas al azar, se produciría el moldeamiento y selección de un corto número de conformaciones.
-Una segunda etapa donde la evolución conformacional sigue llevando la batuta pero permitiendo una dimensión de evolución secuencial, coherente y respetuosa con las conformaciones seleccionadas previamente.
Respecto al surgimiento de la información biológica en el origen de la vida, más que dilucidar la prioridad informativa entre ARN y proteínas, debemos plantearnos: ¿qué fue antes, la información secuencial o la estructural funcional? Si el descubrimiento de las ribozimas (ARN autocatalítico) supuso la inclusión del ARN en el mundo de la actividad enzimática; el descubrimiento de los priones –donde en la propagación de determinados fenotipos proteicos la conformación se impone a la secuencia- ha supuesto el reconocimiento de que algunas proteínas son capaces de almacenar y transmitir información biológica conformacional. El descubrimiento de los priones como agente infeccioso en determinadas enfermedades neurodegenerativas de mamíferos -donde una proteína, el prión, se comporta como un virus- así como determinados procesos de herencia no mendeliana -donde el prión se comporta aparentemente como un gen, por lo que es mejor denominarlo conformón- me animó a proponer un paradigma proteocéntrico, con las proteínas como sujeto principal tanto en el origen de la vida desde lo inorgánico, como en la evolución molecular que subyace a la evolución celular y pluricelular: los priones-conformones actuarían como selectores y propagadores de formas merced a información conformacional. A favor de mi hipótesis de "un mundo de proteínas-conformones primigenio" está también la mucho mayor resistencia y estabilidad de éstos, en comparación con el ARN, frente a ambientes hostiles, como los que se pudieron encontrar en la Tierra primitiva: además de la presencia de aminoácidos en muchos meteoritos, los priones son muy resistentes al calor, a los ácidos, y a las radiaciones ionizantes y UV. Además, se adhieren extremadamente bien y durante mucho tiempo a las arcillas. Además las proteínas, a diferencia del ARN, no presentan problema alguno para su síntesis prebiótica.

Fig. 2. Los conformones en la evolución prebiótica. En la etapa prebiótica, los proteinoides con capacidad para propagar sus conformaciones se debieron seleccionar por: 1) su estabilidad estructural y su capacidad de propagación conformacional; y 2) alguna capacidad enzimática, inicialmente poco específica. Los nuevos conformones pueden seleccionar mejor nuevos proteinodes –con secuencias más parecidas a las suyas y mayor especificidad- y propagar sus conformaciones en una línea de evolución conformacional adaptativa.
Paradójicamente, a partir del establecimiento del código genético -tras un "mundo de ARN autocatalítico" y un "mundo de proteínas-conformones" en coevolución conformacional- aparecería el nuevo marco de la evolución biológica, en el que las proteínas se sintetizan genéticamente, y los ácidos nucleicos son gobernados por las proteínas como instrumento informativo. En este proceso distinguimos tres etapas:
1.- Información conformacional proteínas-ARN. En la coevolución prebiótica, las unidades estructurales proteicas -miniestructuras terciarias procedentes de secuencias cortas compatibles con el cambio conformacional- se fueron seleccionando por su capacidad de interaccionar entre ellas, mediante interacciones débiles no covalentes, formando así miniestructuras cuaternarias más o menos complejas. De igual manera, en esta etapa pregenética, interaccionarían con el ARN formando ribonucleoproteínas; y seleccionando estructuras de uno y otro "mundo" fueron elaborando el código genético: primero conformacional y luego secuencial.
2.- Primera información secuencial proteínas-ARNm, mediada por ARNt y ARNr. Este proceso permitiría la formación de polipéptidos cada vez más largos y eficaces, formados mediante la acumulación de pequeños cambios secuenciales, compatibles y coherentes con el cambio conformacional.

Fig. 3. Inversión del dogma central: de la información conformacional a la secuencial.
Efectivamente, entre las principales ventajas funcionales del código genético tendríamos la transición de estructuras proteicas discontinuas a un único polipéptido formado –de forma rápida y precisa- por la unión secuencial covalente de los aminoácidos de éste. Este proceso se produciría merced a la coselección de dominios proteicos (estructurales y funcionales) junto con determinados fragmentos salteados de las cadenas del ARN ambiental, monocatenario y lineal, que, de esta manera, devendrían en exones.
3.- La información secuencial se almacena en la molécula del ADN, con lo que se garantiza la estabilidad de las conquistas estructurales y una variabilidad secuencial coherente con ellas.
Así, en el paradigma proteocéntrico, la información iría del fenotipo conformacional al genotipo secuencial, invirtiendo, así, el orden del dogma central.
Volviendo a Darwin
Hay más proteínas que genes y, sobre todo, más mensajes fenotípicos que ARNm que, en el paradigma proteocéntrico, resultan de interacciones proteína-proteína y proteína-ligando en rutas funcionales de cambios conformacionales. En el genoma actual convive lo pregenético (ribonucleoproteínas), lo genético (exones-proteínas) y lo epigenético (manejo modular de genes por proteínas).
Así, la información genética estaría en un marco superior de información biológica estructural que incluiría:
- Información conformacional de las proteínas que reside en la disposición singular de sus aminoácidos en su estructura tridimensional.
- Información de la situación espaciotemporal de los elementos o partes de las estructuras biológicas y de la contingencia medioambiental.
Volviendo a Darwin, la selección natural actuaría sobre organismos distinguibles por sus fenotipos, generados mediante interacciones proteicas, que tienen un substrato heredable, tanto genético secuencial como epigenético estructural.
Referencias:
[1] Presentación antigénica y puzzle conformacional. Una hipótesis (I y II). Alfonso Ogayar en Inmunología, vol. 10, nº 1, págs. 19-23, 1991; y vol. 10, nº 3, págs. 97-103, 1991.
[2] Prions: an evolutionary perspective. Alfonso Ogayar, Miguel Sánchez-Pérez en International Microbiology, vol. 1, nº 3, págs. 183-190, septiembre de 1998.
[3] Blog"Estructura e información biológica"
Alfonso Ogayar Serrano
Licenciado en Ciencias Biológicas.
Profesor jubilado.
Mi vocación por la biología marina, y en particular por los microorganismos acuáticos, empezó a muy temprana edad. Aún recuerdo con emoción y asombro la primera vez que vi seres unicelulares a través del ocular de un microscopio. Yo rondaría los 10 años, y el aparato había sido un regalo de cumpleaños de mis padres, que poco pensaron que aquel instrumento rudimentario, hecho de plástico y de mediocre calidad óptica, marcaría mi vida para siempre.

Fig. 1. Diatomea marina. Las diatomeas son algas unicelulares, integrantes del fitoplancton. Son el alimento del zooplancton y de otros organismos. Son especialmente abundantes en zonas ricas en nutrientes, como afloramientos o zonas costeras a finales de invierno y primavera.
A aquel día, tan transcendental en mi vida, siguieron pesquisas y experimentos con tal de descubrir la extraordinaria variedad de las formas de vida acuática. Por facilidad, empecé explorando la flora y fauna microscópica de las aguas dulces; no había riachuelo, estanque o charco que no llamase mi atención. Con los años, fui perfeccionando mi técnica a la par que la calidad de los microscopios que usaba, hasta que me convertí en un aficionado a la microfotografía; fueron mis imágenes del mundo mágico de la vida en una gota de agua las que llamaron la atención de mis profesores. Gracias a eso conseguí una beca predoctoral para estudiar el zooplancton marino. El paso de aguas dulces al medio marino fue todo un reto. La diferencia entre estos dos mundos acuáticos no estriba simplemente en la concentración de sales; el medio marino, debido a su extensión y dinamismo acoge una red trófica mucho más compleja y diversa que la de las aguas dulces.
El plancton y la red trófica marina
Antes de proseguir es preciso que defina algunos conceptos básicos. Por ejemplo, los organismos unicelulares o pluricelulares que habitan en la columna de agua, y cuya escasa capacidad de movimiento les deja a merced de las corrientes, se denominan plancton. La palabra proviene del griego y significa errante. Si bien la mayoría de integrantes del plancton son de pequeño tamaño, también hay excepciones, como las bien conocidas medusas. El plancton se compone, entre otros grupos de organismos, de virus, bacterias, algas microscópicas (el fitoplancton, Fig. 1) y animales (el zooplancton, Fig. 2). Para que os hagáis una idea, en un mililitro de agua (unas 20 gotas de agua) hay, por término medio, 10.000.000 virus, 1.000.000 bacterias, y unas 1.000 o 10.000 algas unicelulares. ¡Pero tranquilos! ni los virus ni las bacterias que os podéis tragar accidentalmente en el mar os van a perjudicar. De hecho, su función en el ecosistema marino es otra. Los virus mantienen controladas las poblaciones de bacterias para que no crezcan en exceso, y estas, a su vez, se encargan de descomponer toda la materia orgánica muerta. Sin bacterias el mar sería un cementerio de cadáveres y excrementos. Las bacterias, al ejecutar su papel como descomponedores, además reciclan nutrientes que son utilizados por el fitoplancton para crecer y hacer la fotosíntesis. Las algas microscópicas que forman parte del fitoplancton son el equivalente de los vegetales terrestres.

Fig. 2. Copépodo marino. Los copépodos son crustáceos diminutos, miembros del zooplancton, que pueblan mares y océanos. Son tremendamente abundantes, incluso más que los insectos en tierra, y su función es clave en el ecosistema marino al ser depredadores del fitoplancton y el alimento principal de las larvas de peces.
Gracias a estos vegetales la mitad de la fotosíntesis del planeta ocurre en el mar. Por consiguiente, debido a la actividad biológica de los organismos del plancton, el papel del océano es fundamental para mitigar los efectos del exceso de CO2 que nos están llevando apresuradamente a un cambio climático. El plancton tiene además otra función, la de alimentar a seres de mayor tamaño, constituyendo de esta manera la base de la red trófica marina. Cada grupo de organismos tiene sus depredadores, que son, a su vez, el alimento de organismos de mayor tamaño. De esta manera la materia y la energía se transfieren hasta los grandes depredadores del mar, los peces carnívoros (atunes, barracudas, tiburones, etc.) y, por supuesto, los humanos. Pero no todo el plancton es beneficioso. Hay determinadas especies de fitoplancton, sobre todo algas dinoflageladas y diatomeas, que son tóxicas y pueden llegar a tener consecuencias graves para el ecosistema. Las agrupaciones de estos organismos se conocen popularmente como mareas rojas, y son la causa de intoxicaciones masivas o muerte de peces, e incluso humanos.
La biología marina, mitos y leyendas
Pero en el mar hay mucho más que plancton. Peces, ballenas, corales, entre otros, son algunas de las maravillas que alberga el mundo marino. De hecho, a la mayoría de las personas al pensar en los biólogos marinos lo primero que les viene a la mente son intrépidos científicos surcando mares y océanos para estudiar ballenas y delfines, o submarinistas expertos analizando la progresión de arrecifes de coral en paraísos tropicales. Estos arquetipos, si bien existen y forman parte de la disciplina, no son lo habitual. Muchos de nosotros trabajamos con organismos que no se ven a simple vista, o con modelos matemáticos de pesquerías, o en el laboratorio estudiando la fisiología o el genoma de una especie en particular. El mar es vasto, pero desgraciadamente los fondos destinados a su estudio son limitados, por no decir escasos (en particular en nuestro país), y en la mayoría de ocasiones el científico vocacional raramente puede elegir a que campo se dedicará. Son más bien las circunstancias de la vida, en ocasiones la suerte, o incluso las tendencias "de moda" en la ciencia, las que marcan el campo en el que terminarás trabajando. Y no os voy a mentir, triunfar en biología marina es duro y requiere muchos sacrificios como veréis a continuación. Pero también os diré que las recompensas son extraordinarias. En mi caso, gracias a la biología marina he viajado por medio mundo, y he estado en lugares mágicos, inaccesibles para la mayoría de la gente, como por ejemplo la Antártida y el Océano Ártico.
Pero cómo se llega a ser un/a biólogo/a marino/a? Para empezar hay que trabajar duro desde la educación primaria hasta la universidad. Si tenéis pretensiones de dedicaros a la investigación, es importante tener un expediente académico excelente para poder acceder a becas. Sin una beca, es muy difícil (por no decir imposible) entrar en un centro de investigación para realizar una tesis doctoral. Un buen biólogo marino, si quiere prosperar en la carrera, necesita saber de todo: matemáticas, física, química, y por supuesto biología. También es imprescindible el conocimiento de lenguas extranjeras, sobre todo el inglés. Todo nuestro trabajo se presenta en inglés, al igual que ocurre en otras disciplinas científicas. Una vez completada la tesis doctoral es recomendable pasar un período (uno o dos años, al menos) en alguna institución de renombre en el extranjero. Si bien durante la tesis doctoral habréis asentado vuestros conocimientos y aprendido las estrategias de publicación, será durante la fase postdoctoral donde se producirá vuestra verdadera especialización y donde se establecerá vuestra proyección internacional. Es muy importante que durante esta fase sigáis publicando intensamente. Al científico, al menos actualmente, se le valora por el número y calidad de sus publicaciones. Por lo tanto, un buen científico tiene que ser un excelente comunicador. Muchas veces, el saber presentar una idea es más importante que la idea en si misma. Pero no os desaniméis, todo se aprende. A la fase postdoctoral le sigue una fase de reincorporación en el país de origen (si es que decidís volver, claro). Muchas veces el obtener un contrato para volver a España se convierte en una tarea titánica, en la que solo los mejores prosperan. Pensad en la carrera científica como en un embudo, donde cada vez se estrecha más el número de gente que puede pasar. Ciertamente, esta selección progresiva de candidatos no es exclusiva de la biología marina, sino que ocurre en todas las disciplinas científicas en mayor o menor medida. La maratón para conseguir un contrato o plaza fija de biólogo marino en este país es larga y ardua, pero si tenéis vocación y sed de conocimiento vais a aprender algo en cada uno de los pasos. La clave está en disfrutar de cada momento y quedarse con lo positivo. Os aseguro que la recompensa, si al fin tenéis éxito, vale la pena.
Para acabar, me gustaría daros un consejo de alguien que ya lleva unos años haciendo investigación. La tendencia actual en esta y en otras disciplinas es ir hacia la super-especialización de la ciencia. Yo os insto a que os intereséis y aprendáis de todo, al igual que aquellos grandes sabios del Renacimiento. Con una visión amplia y global siempre se abordan mejor los problemas y se plantean preguntas más relevantes.
¡Suerte!
Albert Calbet Fabregat
Doctor en Ciencias del Mar; Investigador Científico del CSIC, Instituto de Ciencias del Mar, Barcelona
Mi caso es probablemente uno de tantos de vocación temprana. Pero no creo que estuviera predeterminado para la biología marina, fue una confluencia de factores las que me encaminaron a elegir esta carrera profesional. Del primer factor son culpables mis padres. Desde muy pequeño me llevaron a la playa, y eso ya fue un primer empujón que me puso en el camino (Fig. 1).

Fig. 1. El autor con sus padres en uno de sus primeros días de playa.
Aquello me gustaba, y mucho, sobre todo las zonas intermareales de rocas, que se descubren al bajar la marea. Cuando mis padres decían que nos íbamos a la playa, yo siempre pedía "¡pero que tenga rocas!". Estaba claro, una zona de rocas con la marea baja era un paraíso para alguien con un mínimo de curiosidad. ¿Qué se oculta bajo el mar?, cuando éste se retira por unas horas, con la marea baja, nos permite echar un ojo sin necesidad de mojarnos mucho, apenas los pies. Y ahí se encuentra un buen ejemplo de la vida que albergan los mares y su diversidad.
A este gusto inicial por la fauna que se encontraba a la orilla del mar, en especial los cangrejos, se sumó la suerte que tuve de que todas las profesoras que me enseñaron las asignaturas de Ciencias en la EGB, BUP y COU, fueron unas mujeres muy motivadas y que me contagiaron el interés por la biología. Muchos profesores no son conscientes del efecto que pueden tener en sus alumnos a la hora de reforzar su interés por un tipo de estudios o hacer que los dejen indiferentes y, en el peor de los casos, que los aborrezcan.
Durante todo este periodo de las primeras etapas formativas mi interés por la biología, y en especial la zoología (lo relacionado con el mundo animal), se vio animado por lecturas y programas de televisión. Entre las lecturas tengo que resaltar la "Guía del Naturalista" de Gerald Durrell (Fig. 2) que me regalaron mis abuelos, y con la que empecé a poner nombres a los animales que encontraba en la playa. Y en televisión apareció en esos años un programa, "El hombre y la tierra" presentado por Félix Rodríguez de la Fuente, que marcó a toda una generación. En este programa se nos mostraba la fauna cercana, la que se encontraba en nuestros bosques, ríos, Parques Nacionales, etc. Fue la primera vez que vi lo que significaba estudiar (mediante observación y experimentación) el ciclo de vida y el comportamiento de una especie animal, así como la interrelación entre especies que conviven en un mismo hábitat. Y aquí debo destacar, al igual que antes hacía con la labor de los buenos profesores, el importante papel de los divulgadores científicos. Pueden ser fundamentales para hacer aflorar vocaciones que están ahí, pero necesitan ser despertadas. En mi caso, el empujón definitivo me lo dio otro magnífico divulgador científico, como fue Jacques-Yves Cousteau, y su serie documental televisiva "El Mundo Submarino de Jacques Cousteau". Él fue quien me mostró o, para ser más exacto, quién me sumergió en las profundidades marinas. Ya lo tenía claro, yo quería conocer y ver eso por mí mismo.

Fig. 2. "Guía del Naturalista" de Gerald Durrell.
Yo, desde pequeño, era muy temeroso, cauto o precavido si quisiera utilizar adjetivos más benévolos. El caso es que me daba miedo meter la mano por los agujeros o las grietas de las rocas de la playa, o meterme en el agua donde no veía donde pisaba, o nadar donde me cubría sin saber que nadaba por debajo de mí. Este miedo solo había una forma de superarlo, y era con conocimiento. Saber que animales vivían en esos sitios era la manera de poder disfrutar del mar en plenitud. Por supuesto no perderle el respeto, pero al menos quitarme miedos sin sentido.
Ya estaba claro, quería ser un Jacques Cousteau y viajar por el mundo buceando en todos los mares y conociendo más "a fondo" a sus habitantes. Pero ¿cómo hacía eso?, ¿a dónde podía ir a "apuntarme" para eso?
¿Cómo se hace uno biólogo marino?
Obviamente, durante la enseñanza secundaria opté por las asignaturas de ciencias cuando había optativas, y finalmente cuando acabé COU (lo que hoy día sería segundo de bachillerato), y tras la selectividad, tenía que optar por una carrera que me llevara a mi objetivo. Tenía ante mí un abanico de posibilidades (algo más restringido al que hay hoy) entre el que elegir mi destino: biólogo marino. Actualmente está el Grado en Ciencias del Mar, el más específico para este perfil, y que ofertan en España cinco Universidades públicas (Alicante, Barcelona, Cádiz, Las Palmas de Gran Canaria y Vigo) y una privada (Universidad Católica de Valencia San Vicente Mártir).

Fig. 3. Scandarma lintou, una de las nuevas especies de cangrejo descritas por el autor junto a otros colegas.
Pero por otro lado hay Grados como los de Biología, Bioquímica, Veterinaria, o Ciencias Medioambientales, en los que se pueden estudiar muchas especialidades que conectan con la biología marina. En mi caso opté por la licenciatura de Biología, donde se impartía una asignatura, Zoología, donde esperaba saciar mí interés por los animales, con especial atención a los marinos.
Al acabar era biólogo, pero no había hecho más que empezar a conocer lo que me interesaba, y por eso opté por dedicarme a la investigación, cuyo primer paso era entonces la tesis doctoral. Fue en la tesis donde escogí un tema para meterme de lleno en mi interés principal, aquel que se había despertado de pequeño en mis visitas a las rocas de la playa: los cangrejos (Fig. 3). Entre muchas opciones, escogí el estudiar sus fases larvarias, un tema en el que aún quedaba mucho por conocer. De esta forma regresé a las playas, pero ahora con otra óptica, aumentar mi conocimiento y descubrir aspectos de la biología de aquellos simpáticos animales que despertaron mi interés infantil. Por supuesto, el estudio de la biología marina comprende muchos otros aspectos, no sólo la fauna.
¿A qué se puede dedicar un biólogo marino?
La mayor parte de la superficie del planeta Tierra (un 71%) es agua, y de esta la mayor parte es agua salada de mares y océanos. Por lo tanto parece que, aunque solo sea por su dimensión, es importante conocer este medio con detalle. Y a ese conocimiento podemos aproximarnos desde muchos ángulos. Entre las principales líneas de investigación sobre el mundo marino están la Oceanografía (física, química y biológica), Contaminación, Acuicultura, Ecología marina, Conservación, Microbiología marina, Zoología y Botánica marina, entre otras. En función de la especialidad por la que se opte hay una multitud de diferentes salidas profesionales como: Experto en explotación y gestión de los recursos marinos (por ejemplo, la pesca), Acuicultura, Analista de contaminación marina, Ordenación y gestión litoral, Evaluador del medio marino (informes de impacto), Agente turístico (actividades marinas, subacuáticas, etc.), Divulgador, Genetista marino, Microbiólogo marino, entre otras. También se puede optar por la investigación (básica o aplicada) en cualquiera de los campos antes mencionados, o la docencia, tanto a nivel de enseñanza secundaria como universitaria.
El conocimiento del medio marino es vital para conseguir un crecimiento sostenible, tener océanos sanos y productivos, considerando los problemas que puede generar la actividad humana. Algo más del 50% de la población mundial vive en las zonas costeras, y se espera que sea una cifra que aumente en el futuro. Si a esto sumamos que actualmente el problema del calentamiento global está teniendo uno de sus principales impactos en el medio marino, se puede prever que a futuro serán necesarios muchos profesionales dedicados a este medio, desde diferentes ámbitos, para que ayuden a dar respuesta a los retos que se nos presentarán.
Conclusión desde mi experiencia
En mi caso particular la biología marina ha colmado mis expectativas. El niño que desde los siete u ocho años observaba con interés y curiosidad a los cangrejos de la playa, es ahora un adulto, con más de 50 años, que sigue observando cangrejos en diferentes playas del mundo con el mismo interés y curiosidad, pero con la diferencia de que, en estos años recorridos, y gracias al estudio, reconozco a las especies que me encuentro, se mucho más de sus hábitos de vida y he llegado incluso a descubrir y describir nuevas especies. En este tiempo además he aprendido a cultivar sus fases larvarias, a estudiar su morfología a la lupa y microscopio, y obtener su ADN para conocer las relaciones filogenéticas entre las diferentes especies de cangrejos. El conocimiento que se va obteniendo no hace que se pierda el interés ya que siempre surgen nuevas preguntas, nuevos retos. Y también con los años he encontrado el gusto por divulgar y dar a conocer todo este conocimiento que he ido adquiriendo.
Dedicarte profesionalmente a lo que te gusta y apasiona a nivel personal es una gran ventaja, ya que te permite disfrutar en el desarrollo de tu trabajo. Eso es algo que no todos pueden decir y por lo que yo me siento afortunado y agradecido. Y se lo debo en primer lugar a mis padres que me permitieron y facilitaron dedicarme a lo que me gustaba y a todos los que conocí en este camino (profesores, directores, colegas,…) que me ayudaron y apoyaron.
José A. Cuesta
Doctor en Biología
Científico Titular, Instituto de Ciencias Marinas de Andalucía, CSIC
Crecí en Caudé, un pueblo de 150 habitantes de la provincia de Teruel. Cuando cumplí 10 años pasaron tres cosas que marcaron mi vida: tuve el mejor maestro del mundo, me regalaron un libro que enseñaba a realizar experimentos científicos y me pusieron gafas curiosas.
En esa escuela de pueblo, salíamos a la pizarra y les exponíamos a nuestros compañeros que los humanos somos como unas máquinas: obtenemos energía de los alimentos para gastarla en diversas funciones vitales y actividades diversas. "Si no comes no podrás jugar al futbol" me decía mi abuela. Años más tarde, en el instituto, aprendí que esos alimentos están compuestos por nutrientes, que son las mismas moléculas químicas que forman nuestro cuerpo. En la asignatura de Biología del bachillerato, estudiamos que estas moléculas son las proteínas, los lípidos, los hidratos de carbono, las vitaminas y los minerales. Además, seguimos haciendo experimentos científicos y cada vez me surgían más dudas relacionadas con la alimentación: ¿Qué era realmente lo que nos alimentaba?, ¿por qué insistían tanto en que una dieta saludable y el ejercicio es indispensable para no enfermar?, ¿por qué era tan difícil adelgazar para las personas que tenían sobrepeso u obesidad? y ¿por qué a cada persona le sentaban mejor unos alimentos u otros?
Llego el momento de decidir qué estudiar en la Universidad. Pensé que si los humanos tenemos que comer todos los días, seguro que en el futuro habría un trabajo para alguien interesada en resolver estas cuestiones. Así que me decidí a cursar la Licenciatura de Ciencia y Tecnología de los Alimentos. Salí de mi pueblo y me fui a Valencia. En tercero de la carrera, ya tenía claro que quería ser CIENTÍFICA y dedicarme a la investigación y docencia. Por ello, me gustaría compartir con vosotros algunas de las respuestas científicas a esas preguntas que han guiado mi vida profesional.
¿Qué es un alimento?, ¿y un nutriente? - ¿Qué es realmente lo que nos alimenta?
Los humanos obtenemos la energía mediante la ingestión, absorción, digestión y metabolización de los alimentos. Nuestra dieta es generalmente omnívora, de modo que los alimentos son todos aquellos productos de origen mineral, animal o vegetal que ingerimos. Una vez ingeridos, comienza en nuestro cuerpo el proceso de absorción y digestión, mediante el cual, el organismo obtiene los nutrientes de estos alimentos. Podemos diferenciar entre macronutrientes –forman mayoritariamente los alimentos y proporcionan energía– como proteínas, grasas e hidratos de carbono y los micronutrientes –que se encuentran en menor cantidad, suelen ser esenciales y no aportan energía– como vitaminas y minerales. Así, los nutrientes son todas las moléculas bioquímicas que componen todos los alimentos. Estas moléculas serán metabolizadas por nuestro organismo para la síntesis de nuestras nuevas estructuras moleculares y la obtención de energía. La energía se obtiene por combustión (oxidación) de los nutrientes y proporciona distinta cantidad –medida en calorías– en función de sus características químicas. Todos sabemos que las grasas nos aportan mucha energía (9 kcal/g) y eso es debido a que tienen un elevado grado de reducción. El cuerpo "quema" las grasas gracias al oxígeno que respiramos y obtiene la energía que guarda en los enlaces fosfoanhidro y éster de la molécula de adenosín trifosfato (ATP). Este ATP es como el dinero que usa el organismo en las rutas de síntesis (anabólicas) o degradación (catabólicas). Los hidratos de carbono nos proporcionan menos energía tras la oxidación (4 kcal/g) pero son necesarios para equilibrar el aporte calórico y el tránsito por el tracto digestivo. Las proteínas aportan la misma cantidad de energía que los hidratos de carbono (4 kcal/g) pero son imprescindibles para formar, por ejemplo, músculos, enzimas y anticuerpos. El alcohol no puede ser considerado como un nutriente, ya que tiene efectos tóxicos, pero es una molécula que al oxidarse también proporciona mucha energía (7 kcal/g). De modo que, cuando ingerimos por ejemplo un salmón con patatas (alimentos), estamos digiriendo sus proteínas, grasas, hidratos de carbono, minerales y vitaminas (nutrientes) para formar mediante procesos metabólicos nuevos tejidos musculares (estructuras moleculares) de nuestro cuerpo y obtener ATP (energía).
La pirámide de la alimentación saludable - ¿Por qué insisten tanto en que una dieta saludable y el ejercicio es indispensable para no enfermar?
Hace ya unos 2450 años que Hipócrates relacionó los alimentos con la salud: "Que tu alimento sea tu medicina, y que tu medicina sea tu alimento". Hoy sabemos que la dieta –considerada como el conjunto de alimentos que ingerimos diariamente– determina nuestra buena o mala salud.
La Sociedad Española de Nutrición Comunitaria; SENC publicó recientemente un artículo científico [1] donde se muestra la nueva pirámide de la alimentación saludable (Fig. 1). Esta edición actualizada, responde a las nuevas investigaciones científicas realizadas en materia de biología molecular y bioquímica nutricional. Podemos ver que en la base de esa pirámide, no tenemos alimentos, sino hábitos de vida saludable. Así, el ejercicio físico es el factor más importante, ya que regula la ingesta y ayuda al mantenimiento del equilibrio energético. Es recomendable que cada persona ajuste su ingesta calórica (las calorías que ingerimos) a sus actividades diarias (las calorías que gastamos) con el objetivo de mantener un balance neto nulo.
Gracias a la Ciencia he trabajado en distintas partes del mundo –como Japón, EEUU, India y Bélgica– donde pude experimentar lo diferentes que son las dietas y hábitos de sus habitantes.

Fig. 1. Pirámide de la Alimentación Saludable. Sociedad Española de Nutrición Comunitaria (SENC), 2015.
Aunque proporcionen la misma cantidad de energía, existen muchos otros factores que definen su salud nutricional, como son el tipo de cocinado, el tipo y cantidad de las grasas, la calidad proteica medida como cantidad de aminoácidos esenciales, la cantidad de frutas y verduras o el ejercicio diario que practican.
La mejor forma de adelgazar es no engordar - ¿Por qué es tan difícil adelgazar para las personas que tienen sobrepeso u obesidad?
Todos sabemos que, si comemos más de lo que gastamos, engordaremos. Por el contrario, si comemos menos, no tendremos suficientes calorías para cubrir las necesidades fisiológicas de nuestro cuerpo y, adelgazaremos. Aunque esta afirmación es generalmente cierta, muchos otros factores influyen en la regulación del peso. Esos factores –hormonales, genéticos, emocionales y evolutivos– son los que definen el grado de dificultad de las personas para ganar o perder peso. Actualmente, los humanos ingerimos alimentos varias veces al día. Pero esto no ha sido siempre así. La raza humana dejó de ser nómada y comenzó a vivir de la agricultura y ganadería hace tan sólo unos miles de años. Por lo que existían grandes aportes calóricos puntuales (caza de un gran animal) seguidos de periodos de hambre que definieron genéticamente los procesos metabólicos y su regulación. Esas moléculas encargadas de la regulación – como la leptina– ayudan a mantener el peso óptimo (peso de ajuste) y provocan que tengamos sensación de hambre o saciedad. ¿Qué ocurre cuando una persona que pesaba X Kg engorda 10Kg? Pues que desplaza su peso de ajuste a un nuevo valor mayor (X+10). Cuando pretende adelgazar, todas las señales bioquímicas reguladoras están indicando una situación de alarma: ¡Atención!, –grita nuestro organismo– necesitamos más calorías para llegar a ese nuevo peso de ajuste (X+10). El organismo identifica ese peso mayor como óptimo, aunque esté muy por encima de un peso saludable. El cuerpo siente lo mismo que nuestros ancestros tras un periodo de caza y posterior carencia alimentaria. Cuando nos situamos por debajo del peso de ajuste (X-5), el organismo responde disminuyendo el gasto energético y produciendo señales para aumentan la ingesta de alimentos. Es decir, el organismo reduce su gasto y tenemos más hambre. Es por ello, que se produce el conocido como "efecto rebote" tras abandonar una dieta de adelgazamiento.
Nutrigenómica y nutrigenética. Lo más nuevo - ¿Por qué a cada persona le sientan mejor unos alimentos u otros?
Actualmente, existe un aumento notable de las dolencias relacionadas directamente con la alimentación, tanto en niños como en adultos. Entre ellas encontramos la obesidad, el síndrome metabólico o distintos tipos de cánceres. Todas ellas suelen responder a un patrón de dietas poco saludables y falta de ejercicio. Sin embargo, hoy sabemos por estudios genéticos que, no todos los seres humanos respondemos igual ante los mismos nutrientes. Por ello, se están desarrollando dos novedosas disciplinas que estudian a) el efecto molecular de los nutrientes sobre la expresión de los genes –Nutrigenómica– y b) los efectos metabólicos o enfermedades que provoca una dieta en las personas con determinadas variaciones genéticas o mutaciones –Nutrigenética–. Ambas disciplinas combinan novedosas técnicas tanto de biología molecular como informáticas para el estudio de la interacción entre nutrientes y genes. Como veis, la Ciencia siempre hace uso de todos los avances tecnológicos para avanzar rápido en el conocimiento, en este caso de la biología. Muy pronto, cada persona podrá adaptar automáticamente su ingesta calórica diaria a sus gastos energéticos personales. Además, podrá conocer exactamente el efecto de todos los nutrientes en su organismo y como su organismo –genoma– responde a esos nutrientes, consiguiendo que su alimentación sea la más adecuada.
Encontré las respuestas a estas preguntas mientras cursaba un doctorado y viajaba por todo el mundo trabajando como investigadora. Actualmente desarrollo mi profesión como profesora de la Universidad Politécnica de Madrid, sigo llevando gafas curiosas, haciendo Ciencia y no dejo de aprender todos los días junto a mis alumnos. Y a medida que avanzamos en ese conocimiento nos surgen nuevas preguntas. Esas preguntas son las que podréis responder vosotros. En el caso de la bioquímica nutricional, será necesario integrar los conocimientos bioquímicos con el análisis computacional de los millones de datos biológicos generados, desde el análisis de metabolitos proteicos hasta la secuenciación masiva de genomas. Y me pregunto, ¿por qué no puedes ser tú uno de esos jóvenes científicos? ¿Por qué este libro no puede marcarte la vida, como lo hizo mi libro de experimentos? ¿Te animas a ponerte las gafas de la curiosidad para llegar a ser un@ buen@ científic@?
Sigue leyendo el libro, ¡esta es tu oportunidad!
Referencias:
[1] Grupo Colaborativo de la Sociedad Española de Nutrición Comunitaria (SENC): Aranceta Bartrina J, Arija Val V, Maíz Aldalur E, Martínez de Victoria Muñoz E, Ortega Anta RM, Pérez-Rodrigo C, Quiles Izquierdo J, Rodríguez Martín A, Román Viñas B, Salvador i Castell G, Tur Marí JA, Varela Moreiras G, Serra Majem L. Guías alimentarias para la población española (SENC, diciembre 2016); la nueva pirámide de la alimentación saludable. Nutr Hosp 2016;33(Supl. 8):1-48. DOI: http://dx.doi.org/10.20960/nh.827
Eva Miedes Vicente.
Profesora Ayudante Doctor.
ETSI Agronómica, Alimentaria y de Biosistemas. Dpto. Biotecnología-Biología Vegetal, Universidad Politécnica de Madrid.
Centro de Biotecnología y Genómica de Plantas (CBGP) UPM-INIA
Sí, yo quiero ser biotecnóloga, quise ser biotecnóloga y gracias a ello soy la que soy hoy en día. Pero, ¿por qué ser biotecnólogo/a y no cualquier otra salida profesional?
Para intentar responder con más contundencia a esta pregunta, y para encontrar valores más allá de los sentimientos y de ese "algo" que te lleva a tomar determinadas decisiones en la vida, he planteado esta pregunta a mis alumnos y alumnas. Han sido varios los que han respondido a la pregunta cuestionando qué es la biotecnología; otros han indicado la novedad y expectativa de tener muchas salidas profesionales al ser una carrera universitaria relativamente novedosa y hay quien ha indicado que sería biotecnólogo/a para investigar; unos pocos/as han resaltado la idea de poder "crear inventos" (sobre todo medicamentos, y sobre todo la cura para el cáncer) y la han relacionado con esta profesión; y alguien ha indicado que para disfrutar tanto como lo hago yo ejerciendo mi profesión.
Bio ¿qué?
Si hubiera podido contar las veces que me han formulado la pregunta que da título a este apartado… Aún hoy en día, a menudo, cuando me preguntan qué he estudiado o a qué me dedico, y respondo con la pablara biotecnología o biotecnóloga, debo responder a esta pregunta…
La biotecnología es una ciencia multidisciplinar encargada del estudio y explotación de la materia biológica, los procesos y los sistemas encontrados en la naturaleza para explorar sus usos de una manera eficiente y mejorar la calidad de nuestras vidas.
Ante tal definición, queda patente que la biotecnología ha existido siempre. Así, procesos como la fabricación de vino, pan, queso o yogurt, son y han sido biotecnología, la denominada hoy en día biotecnología tradicional.
La biotecnología de los colores. Los colores de la biotecnología. Aplicaciones.
Ante la definición del apartado anterior, por tanto, la biotecnología no es una nueva ciencia, sino una ciencia multidisciplinar, que compendia múltiples ámbitos de múltiples ciencias de múltiples sectores. Así, se definen los colores de la biotecnología como las aplicaciones o ámbitos en los que interviene, que como se podrá ver, son muchos y muy variados:

Fig. 1. Algunas ramas que intervienen en la interdisciplinariedad de la Biotecnología.
-Verde: ámbito de la agricultura como campo de explotación. En este color la biotecnología se encarga de la generación de nuevas variedades de plantas de interés, alimentos, biofuel, biofertilizantes y biopesticidas…

Fig. 2. Clasificación de la biotecnología por colores.
Color controvertido en algunos aspectos dado los movimientos a favor y en contra de la transgénesis (los famosos OGMs, transgénicos u organismos genéticamente modificados).Pero también muy importante para la obtención de medicamentos de alto valor, con interés médico, biosanitario o industrial.
-Azul: en el que la biotecnología explota los recursos del mar para la obtención de productos con interés industrial. Aunque es aún un color por investigar con mayor profundidad y explotar, ya han sido muchos los medicamentos y, sobre todo, cosméticos, obtenidos a partir de esta fuente.
-Gris: en este caso la biotecnología trata de obtener beneficios a partir del medio ambiente, desarrollando profundamente, y más en los últimos tiempos, técnicas y métodos para el mantenimiento de la biodiversidad (incluyendo técnicas de clonación, almacenamiento de genomas, etc.) y la eliminación de elementos contaminantes, conocido como biorremediación (empleo de microorganismos para la eliminación de compuestos no deseables).
-Blanco: o biotecnología industrial (en industria textil, química, papelera, entre otras), en la que se intenta que los procesos sean más eficientes o menos contaminantes y se producen e investigan nuevos materiales menos contaminantes en vista al mantenimiento sostenible de nuestro planeta.
-Rojo: ámbito en el que la biotecnología se encuentra inmiscuida en la medicina (y de la que es base fundamental), en la que trata de desarrollar e investigar nuevos medicamentos, nuevas vacunas y antibióticos, nuevas enfermedades, terapias, etc. Como ejemplo de técnicas que se emplean en los hospitales de nuestras ciudades tenemos la terapia génica o la medicina regenerativa, entre otros, que tan buenos resultados están aportando y salvando tantas enfermedades y vidas.
Biotecnólogos/as
La biotecnología ha existido siempre, pero, ¿las personas que la empleaban eran biotecnólogos/as? Algunos definen a los biotecnólogos (o conocidos como biotecs) como profesionales que "estudian la biología, la ciencia de los seres vivos, asociada a la tecnología". Pero realmente son los que se encargan, nos encargamos, del desarrollo y aplicación de diferentes técnicas que nos permitan explotar la materia biológica, así como los procesos y sistemas que existen naturalmente en nuestro entorno, en nuestra naturaleza, para obtener beneficios y mejoras aplicadas al ser humano y su entorno. Por tanto, hasta que no surgió la carrera universitaria especializada, la biotecnología, los que la ejercían o empleaban, con o sin conocimiento real sobre ella, de manera tradicional, no eran catalogados como biotecnólogos/as.
Pero ahora ya sí podemos serlo, de manera que si tú quieres serlo, y te decides a estudiarlo en España, te conviene saber que puedes hacerlo en las Universidades de Madrid, Valencia, País Vasco, Zaragoza, León (ciudad donde comenzó esta no nueva profesión), Elche, Oviedo, Sevilla, Barcelona, Murcia, Extremadura, Cádiz, Almería, Salamanca, Lleida o Vitoria, entre otras…Eso sí, no olvides que la nota de corte llega a ser de 12,5 puntos en algunos casos. Y que tendrás asignaturas de múltiples ámbitos de estudio (algebra, cálculo, química, física, fisiología, medicina nuclear, radiodiagnóstico, informática, entre otras…) y múltiples prácticas de laboratorio (aunque dependerá de los planes de estudio de cada universidad en concreto) en las que podrás averiguar en qué color deseas especializarte y qué aplicación futura desear fomentar.
¿Para qué?
Hay quien relaciona la biotecnología con la idea de ganar dinero, de ser autor de algún medicamento que salve a muchas personas y te haga ganar mucho dinero, o con la idea de crear alguna aplicación o técnica con un gran ámbito de aplicación. Hay quien relaciona esta profesión con docencia e investigación en general. Aunque se debe tener en cuenta que en el ámbito de la investigación son muchos los/as profesionales de la Química, Física, Biología, Medicina, e Ingeniería, entre otras ramas, que se dedican a aplicar sus conocimientos para avanzar en ciencias, para desarrollar nuevos productos, nuevos materiales, nuevos dispositivos, etc.; y esto es porque de la combinación de conocimientos de múltiples áreas es de donde surgen proyectos, ideas, prototipos, modelos y productos con fundamento, con éxito.

Fig. 3. Fotografía de trabajo en el laboratorio
Sin embargo, toda profesión a la que decidas dedicar tu vida es todo eso y mucho más. Mucho más que dinero, mucho más que determinados logros puntuales, mucho más que un trabajo con el que pasamos los días hasta nuestra jubilación. La pasión que sentimos por nuestra profesión es ese "algo" que nos remueve, que nos hace que nos sintamos especiales ejerciendo, desarrollando una labor y no otra. Ese "algo" que hace que seamos mejores, los mejores de acuerdo a nuestras posibilidades. Dicen que es bueno guiarse por los sentimientos, por las intuiciones, por las corazonadas que te indican que algo irá bien, siempre que la razón te lo consienta. Y es que, ante todo, además de conceptos, procedimientos y conocimientos de los que somos responsables los profesores para con nuestro alumnado, el lema que siempre intento transmitir es "hagas lo que hagas, hazlo con pasión". Así, elige siempre razonada y pasionalmente cada una de las decisiones que debas tomar en la vida, y más aún la de tu futuro profesional, en definitiva, tu vida.
Mayte Conejero Muriel
Doctora en Cristalización y Cristalografía
Biotecnóloga y Profesora de Secundaria y Bachillerato
-¿Qué es esto verde que has puesto a crecer en la placa?
-¿Esto? Son células vegetales sin diferenciar, por eso no tienen forma. ¿Pero sabes una cosa? Son totipotenciales. Ahora le vamos a dar buenas condiciones para crecer y dependiendo de qué hormonas le suministremos haremos que se convierta en una raíz o en un tallo.
-¡Madre mía!, pero entonces, ¿es que puedes convertirlas en lo que tú quieras?
- Pues claro, esto es Biotecnología.
Este fue mi primer contacto con la biotecnología vegetal, y la verdad es que a mí aquello me pareció magia. Por aquel entonces yo ya estaba en la facultad estudiando Biología donde había entrado motivada por mi interés en la Genética y en la Biología Molecular en general, sin embargo desconocía todo el potencial que la Biotecnología me iba a ofrecer.
En todas las disciplinas de la ciencia podemos encontrar algo de ciencia ficción, incluso como se dice muchas veces, que con la realidad se llega mucho más allá de lo imaginado, y la Biotecnología tiene mucho de esto. Como su propio nombre indica la Biotecnología es la aplicación tecnológica de los organismos vivos (o de sus derivados) para poder crear o modificar productos o procesos que tengan diferentes usos. Esta es la definición oficial que se cita en la Convention on Biological Diversity, Article 2. Use of Terms, United Nations. 1992. Seguramente como a mí, ésta definición no os habrá aclarado mucho y os hagáis todavía un montón de preguntas. Por un lado tenemos entonces los seres vivos, y por el otro cualquier desarrollo tecnológico o industrial que queramos combinar con los primeros, ¿y esto para qué sirve?... En realidad esta pregunta es muy difícil de responder y a la vez es lo que hace que sea un campo de estudio tan interesante, ya que la Biotecnología puede tener tantos usos como ideas se nos ocurran. De hecho es un campo tan amplio que vais a oír muchas veces hablar de la Biotecnología nombrada por colores para poder diferenciar entre distintas áreas. Así, a grandes rasgos, es habitual oír hablar de Biotecnología roja cuando el campo de estudio se centra en la medicina, Biotecnología gris si es sobre medio ambiente, Biotecnología azul cuando se ocupa del medio marino, Biotecnología blanca la involucrada en los procesos industriales y Biotecnología verde la centrada en agricultura. A primera vista es lógico pensar que la Biotecnología de plantas es una Biotecnología verde por definición, al fin y al cabo las plantas son verdes, ¿no?, pero en realidad las plantas son organismos tan interesantes que llegan a abarcar toda la escala de colores.
¿Qué es la Biotecnología de plantas?
La Biotecnología de plantas, también conocida como Biotecnología vegetal, es una rama de la biología que nos proporciona un campo de estudio que está en auge desde hace pocas décadas, aunque en realidad sus inicios son tan antiguos que se remontan a la elaboración del pan, de la cerveza o los injertos en agricultura para obtener nuevas variedades de frutas. Combina las plantas con procesos tecnológicos pero poco tiene que ver en realidad con el propio cultivo de las plantas, sino más bien con el entendimiento de su biología para mejorarlas y/o aprovecharlas como herramientas para su uso industrial.
¿Qué es un biotecnólogo vegetal?
Los biotecnólogos somos esencialmente biólogos moleculares que nos valemos de otras disciplinas como la Ingeniería genética, la Bioinformática o la Virología (entre muchas otras) para poder editar la información genética de los organismos vivos, en este caso, de las plantas. Nuestro trabajo, ya sea en una Universidad investigando o en una empresa lo realizamos esencialmente dentro de un laboratorio. Ocasionalmente podemos hacer trabajo de campo, pero en algún momento volvemos a ponernos la bata blanca. Pero esto no es para nada aburrido, ¿o acaso en el reparto de la película el personaje más interesante no es siempre el del científico/a?
¿Qué es lo que podemos hacer los biotecnólogos de plantas?
Los biotecnólogos vegetales conocemos la fisiología y la anatomía de las plantas y la aprovechamos para hacer mejoras en muchos sentidos. Queremos, por ejemplo, mejorar los cultivos, con el fin de obtener cosechas más abundantes, más frutos y más sabrosos, más resistentes a las enfermedades, al estrés que éstas sufren por el entorno (conocido como estrés abiótico) o a las plagas de virus o insectos, o que su cultivo requiera condiciones para crecer menos exigentes y así poder sembrarse en zonas del planeta desfavorables o con pocos recursos. ¿Os imagináis desarrollar un alimento súper completo que pueda combatir la desnutrición y sea barato de obtener?, ¿cereales que puedan alimentarse del aire?, ¿plantas biónicas a partir de nanomateriales que sustituyen a la luz eléctrica? Pues sí, todas estas plantas ya existen gracias a la Biotecnología. Aunque también podemos hacer cosas chulas aunque menos transcendentales como plantas ornamentales fluorescentes que brillan en la oscuridad, o sandías sin pepitas. Todo depende de la idea que se tenga en la cabeza y del interés que pueda haber en el mercado para que financien tu proyecto.
Pero como hemos dicho antes, los biotecnólogos de plantas no nos centramos sólo en la mejora de las plantas en sí mismas para agricultura o alimentación, sino que también aportamos importantes descubrimientos en ecología y medicina. En biorremediación por ejemplo, conocida en nuestro sector como fitorremediación, permite, gracias a la cualidad que tienen las plantas de absorber múltiples sustancias, limpiar una zona contaminada con metales pesados o radiactivos de forma fácil y rápida, barata y que genera pocos residuos. Otro ejemplo son los biocombustibles, que son especialmente importantes porque reducen el volumen total de CO2 que se emite en la atmósfera y son una alternativa muy beneficiosa para al medio ambiente. También la producción de compuestos de interés industrial es un área en auge. Hablamos aquí de celulosa, textiles, cosméticos o plásticos.
¿Y en medicina? Tradicionalmente las plantas han sido un aliado para combatir las enfermedades humanas, pero la biotecnología va un poquito más lejos de lo que conocemos como plantas medicinales. Las plantas que nosotros hacemos están modificadas genéticamente para producir proteínas de diseño, anticuerpos y vacunas, lo que da lugar a multitud de medicamentos. Por poner un ejemplo, así se ha obtenido una vacuna efectiva contra el ébola u hormonas como la hormona del crecimiento que podemos usar en personas y tienen la misma actividad que las que produciría nuestro propio cuerpo. ¿Esto quiere decir que las plantas pueden producir proteínas iguales a las humanas? Sí, pueden. Y esto ha dado lugar al uso de las plantas como biofactorías. Plantas que producen proteínas de diseño a nuestro gusto. No me podéis negar que esto no parece ciencia ficción.
¿Por qué vas a querer ser biotecnólogo de plantas?
Es un campo aplicado que nos permite trabajar en áreas muy diferentes como la ecología, la alimentación o la sanidad. Combina investigación con industria pudiendo desarrollar todo tipo de proyectos que tienen una utilidad directa, lo cual es muy reconfortante para los que nos gusta saber qué puede hacerse con los resultados de nuestras investigaciones. Además vuestros proyectos muchas veces parecerá que rozan la ciencia ficción y esto os va a permitir desarrollar toda vuestra creatividad.
Y no me podéis negar que las plantas son un regalo; no sólo producen oxígeno, son bonitas, nos ayudan a sanar, nos alimentan… además cuando hemos podido ver a nivel microscópico hemos descubierto que sus células son una fuente productora ideal. Imagínate todo lo que te queda por descubrir.
Let’s go Magic, let’s go Science!
Silvia Jurado Sánchez
Doctora en Biología
Project Manager en AGRENVEC, S.L.
Cuando yo le dije a mi madre en mi Pontevedra natal que quería estudiar Ciencias del Mar, en junio de 1990, mi madre me preguntó "¿Ciencias del Mal?, pero ¿eso para qué es?, ¿para leer la mano?" Así era de desconocida la carrera cuando me picó el gusanillo de estudiar el mar. Desde aquel día hasta hoy, mucho ha llovido. Finalmente hice mi carrera de 5 años en la Universidad de Cádiz. Para los que penséis que estos estudios universitarios se tratan de Biología Marina, estáis muy equivocados. Nada más lejos de la realidad. La carrera de Ciencias del Mar viene a ser como una mesa de cinco patas, cada una de ellas representada por las cinco ramas de la ciencia necesarias para entender el mar desde una perspectiva multidisciplinar: matemáticas, física, química, geología y biología. Pensar que el mar es la parte más extensa de nuestro planeta Tierra, y que se encuentra en constante interacción con la atmósfera y con los continentes y los fondos marinos. Al ser un ambiente tan dinámico, es necesario estudiar tanto su estado general como los cambios que se producen a diferentes escalas temporales y espaciales, algo imposible de hacer sin la ayuda de las matemáticas y de la física.
Cuando estaba estudiando mi tercer año de Ciencias del Mar entré como alumna colaboradora en el grupo de Ecología del Departamento de Biología Animal, Vegetal y Ecología. Gracias a la labor que hacía en dicho grupo, una vez era Licenciada en Ciencias del Mar, y el mismo día que era la Graduación, me embarqué en mi primera campaña oceanográfica "IctioAlboránCádiz 95", la cual se desarrollaba durante un mes en el mar de Alborán, el estrecho de Gibraltar y el golfo de Cádiz. Ese fue mi bautismo real en la vida científica marina, estando a pie de cañón en la vorágine de una campaña, con otros científicos, tomando decisiones, muestreando, analizando, trabajando jornadas de 14-16 horas. Con los datos obtenidos de dicha campaña, realicé mi Tesis de Licenciatura, con cuya defensa obtuve el título de Licenciada con Grado en Ciencias del Mar.
Gracias a la obtención de una beca del Ministerio de Educación y Ciencia, pude desarrollar mi Tesis Doctoral sobre un tema muy vinculado al papel que hacen los océanos para mitigar el efecto invernadero: el proceso de formación de agregados marinos, que es uno de los procesos de los que consta la bomba biológica de carbono.

Fig. 1. Fotografía tomada en una Campaña Oceanográfica. ¿Quién se apunta?
Esta bomba biológica consiste en que gracias a la fotosíntesis realizada por el fitoplancton en las capas superficiales del océano, y donde la concentración de dióxido de carbono está en equilibrio con la atmósfera, esta nueva biomasa algal, cuando llega el final del periodo que se conoce como floración del fitoplancton, comienza a adherirse hasta generar agregados de mayor tamaño que las células individuales de fitoplancton. Estos agregados sedimentan a mayor velocidad y se produce un transporte de carbono desde las aguas superficiales hacia las aguas profundas. De esta manera, se "secuestra" el carbono y queda separado su contacto con la atmósfera en escalas de tiempo desde décadas a centenas de años. Para la realización de mi Tesis Doctoral, participé en numerosas campañas oceanográficas (en el océano Pacífico, en el Atlántico y en el mar Mediterráneo) y realicé varias estancias en centros de investigación extranjeros (IFM en Kiel, Alemania; Universidad de Hawaii y Universidad de Columbia en Nueva York).
Tras la defensa de mi Tesis Doctoral, obtuve una beca Postdoctoral del Ministerio de Educación y Ciencia, para realizar investigación en la interacción de la oceanografía física con la oceanografía biológica, en el Lamont Doherty Earth Observatory de la Universidad de Columbia de la ciudad de Nueva York. Durante esta etapa de mi vida tuve acceso a tecnología de última generación para poder investigar como un fenómeno físico como es la existencia de un frente de plataforma, afecta a la producción primaria y por tanto a la cadena trófica. Pero, ¿qué es un frente de plataforma? La mejor manera de explicarlo es intentar visualizarlo. Sabéis que en el Atlántico Norte se encuentra la famosa Corriente del Golfo, tan empleada por los navegantes desde hace centenas de años, y que es responsable del clima tanto en Europa como en la costa este de América del Norte (Canadá y Estados Unidos de América). Pues dicha corriente, cuando va hacia el sur en el oeste del Atlántico Norte, y a una distancia de la costa donde el fondo marino empieza a tener mayor profundidad (lo que se conoce como borde de la plataforma continental), genera un fenómeno físico por el cual, aguas profundas más ricas en nutrientes, suben hacia profundidades menores donde existe suficiente luz para que las células del fitoplancton puedan realizar la fotosíntesis. De esta manera se produce una "fertilización" de las aguas superficiales. Para poder estudiar este fenómeno se emplearon desde colorantes que eran fluorescentes y se podía estudiar su dispersión por el mar, hasta sensores que enviaban datos y agua casi a tiempo real a la cubierta del barco oceanográfico, donde el grupo de científicos a bordo tomábamos numerosas variables para estudiar este efecto fertilizador.
Mientras estaba realizando mi estancia Postdoctoral en Nueva York, fui invitada a participar en una campaña en la cuenca Guaymas, en el océano Pacífico en la zona de Baja California, para estudiar el proceso de agregación pero en un ecosistema que se sustenta por un motor totalmente distinto al habitual: las fuentes hidrotermales profundas. Si normalmente en los ecosistemas marinos los eslabones más bajos de la cadena trófica comienzan con el fenómeno de la fotosíntesis, en el caso de las fuentes hidrotermales profundas el motor es la quimiosíntesis realizada por bacterias que son capaces de utilizar los compuestos químicos que lleva el agua de mar a muy elevadas temperaturas y que ha sido transformada y enriquecida al pasar cerca de zonas activas volcánicamente. La participación en esta campaña me permitió hacer algo extraordinario como fue bajar a 2100 m de profundidad en el batiscafo ALVIN y ver con mis propios ojos dicho ecosistema.
Pero mi actividad como científica marina ha continuado evolucionando y cuando me reincorporé a la comunidad científica en España, mi línea de investigación la enfoqué en una temática con un impacto claro en la sociedad en la que vivimos: las medusas. Dada mi experiencia en la oceanografía biológica, mi estudio sobre estos fascinantes organismos gelatinosos se realiza desde una perspectiva multidisciplinar, abordando la dinámica de poblaciones de estos organismos teniendo en cuenta desde los fenómenos meteorológicos, hasta los climáticos y oceanográficos.
La profesión de científica marina es apasionante. Requiere dedicación, esfuerzo y vocación. Es un trabajo que te permite realizar parte del mismo en el laboratorio, otra parte en salidas al mar, de corta duración o de semanas en campañas oceanográficas, y la mayor parte de tu tiempo te encuentras en tu mesa con tu ordenador estudiando los trabajos de otros investigadores, pensando en nuevas ideas, analizando tus propios resultados e intentando cristalizar tu investigación en publicaciones científicas que aporten nuevo conocimiento sobre el mar.
Laura Prieto Gálvez
Doctora en Ciencias del Mar; Investigadora Distinguida del Instituto de Ciencias Marinas de Andalucía (Consejo Superior de Investigaciones Científicas, CSIC)
Cintas de Möbius de Grafeno en el Jardín Botánico
No puedo evitar estar nervioso, a pesar de decenas de conciertos anteriores con diferentes bandas y en diferentes escenarios, mientras espero a mis compañeros de Within Experimental Error (Fig. 1) en el Jardín Botánico de Madrid.

Fig. 1. Logo de Within Experimental Error (W.E.E.)
Hoy es un concierto muy especial, aunque siempre lo sean: hoy actuamos en la Noche de los Investigadores, poniendo ritmo a un evento con una clara vertiente científica y divulgativa organizada por el CSIC. Debería estar en mi salsa, es ciencia y es música y yo participo en ambas, como público asistiendo a un encuentro con un neurocientífico y, encima del escenario, como miembro de la banda de Jazz, Funk y Rythm & Blues del Instituto de Ciencia de Materiales de Madrid [1]. Cuando por fin veo llegar a mis compañeros cargados con los instrumentos, me sorprende ver a Fito (Adolfo González Grushin, físico teórico, guitarrista, cantante, trompetista y showman) no solo relajado sino muerto de risa: "MSax, tengo una propuesta de colaboración: cintas de Moebius de grafeno. Tú las sintetizas y yo calculo las propiedades que tendrán. ¡A lo mejor nos dan el Nobel! Eso sí, lo difícil va a ser tu parte."
La banda
Durante cerca de siete años, esta banda que montamos sin muchísimas expectativas más allá de pasarlo bien Simone Fratini, físico teórico, bajista y contrabajista, y yo, químico experimental y saxofonista, creció y se consolidó, a pesar de continuos cambios en su formación motivados por la movilidad característica del personal investigador. Los doctorandos (Alex, Ainhoa, Fito, André, Marcos, Wagner, Álvaro G., Carlos y Fer) terminaron sus tesis y emprendieron la "aventura postdoctoral", que es como llaman los cursis a salir al extranjero a buscarse la vida y seguir aprendiendo. Y los postdocs (Gladys y Luis) terminaron sus estancias y emigraron buscando un futuro. El propio Simone volvió a su instituto del CNRS en Grenoble, donde continúa una muy activa vida científica y musical.

Fig. 2. W.E.E. en CSIC Central, 13/07/2010 (Fer, Ainhoa, Gladys, Fito, Alex y Miguel)
Para encontrar el tiempo, entre tesis y papers y experimentos y cálculos, nos escapábamos a la hora de comer a un local de ensayos que pagábamos entre todos, muchas veces tomando un bocadillo durante el camino en lugar de la comida. Tocábamos en celebraciones de nuestro instituto y del CSIC Central, y también en fiestas privadas. En nuestros mejores momentos llegamos a sonar francamente bien. Nos entrevistaron en varias ocasiones y llegamos a tocar en vivo, batería incluida, en el programa de la cadena SER Carrusel de Verano, de Alberto Granados. Como norma general, causaba sorpresa una banda de músicos-científicos.
Ciencia y música
¿Por qué la sorpresa? Yo no lo sé, y no quiero pensar que, en general, se considere a los científicos gente distraída y despistada, encerrada en su torre de marfil, incapaz de dejar de pensar en electrones, pterodáctilos, números de oxidación, retículos endoplasmáticos, hipernovas y ecuaciones dificilísimas. Los ejemplos de músicos-científicos, o científicos-músicos, son tan abundantes que me da pereza siquiera relatarlos, aparte de que no quisiera dar la impresión de que pretendo compararnos con nadie. Pero habrá que mencionar unos pocos ejemplos, para sacudir el polvo a esas posibles concepciones tan alejadas de la realidad.
Por ejemplo, diré que el gran William Hershel, entre otras cosas descubridor de los rayos infrarojos y de Urano, fue un multiinstrumentista virtuoso y un compositor muy reconocido antes de decidir dedicarse junto a su hermana Caroline, cantante soprano, a la astronomía. O que Alexander Borodin, uno de los compositores del Club de los Cinco, representantes del romanticismo nacionalista ruso, se ganaba la vida como profesor de química. O que Elgar, la quintaesencia de la música británica (hablamos, obviamente, de la etapa previa a los Beatles) era un gran aficionado a la química y tenía su propio laboratorio casero (The Ark), en el que desarrolló un aparato para la producción de sulfuro de hidrógeno que patentó y comercializó. Y que, si bien la pasión de Einstein por el violín es muy conocida, quizá no lo sea tanto que el padre de la física cuántica, Max Planck, era un consumado pianista que hubo de decidir en su juventud si se dedicaba a la música o a la física. Eso mismo sucedió a Ilya Prigogine, físico-químico estudioso de los sistemas complejos y de la termodinámica alejada del equilibrio. Y quizá se desconoce que el gran Fletcher Henderson tuvo que ganarse la vida como pianista, compositor, arreglista y líder de Big Band porque un químico y matemático, siendo negro, no tenía grandes oportunidades en la época y lugar en los que le tocó vivir. Terminó contribuyendo de una manera sobresaliente al desarrollo de la orquestación del Jazz, a la definición del género Swing y a la propia concepción de la Big Band.
Pero los ejemplos no están solo en la música clásica o el Jazz: Brian May, guitarrista de Queen, es doctor en astrofísica y Mike Einziger, guitarrista de Incubus y Time Lapse Consortium ha cursado estudios de historia y filosofía de la física. Y en España el músico Antonio Arias, de Lagartija Nick, y el astrónomo y agitador científico-cultural José A. Caballero, del Centro de Astrobiología (INTA-CSIC), han creado el proyecto "astro-musical" unitedsoundsofcosmos como instrumento de divulgación y educación, con participación de un gran número de músicos [2]. Otro ejemplo interesante es el de Ramón López de Mántaras, director e investigador del Instituto de Investigación en Inteligencia Artificial (IIIA) del CSIC. Ramón no solo es pianista y un gran aficionado al Jazz, además investiga, entre otras cosas, en la aplicación de la inteligencia artificial a la síntesis de música expresiva. El programa SaxEx del IIIA es capaz de generar interpretaciones de saxo tenor alegre o triste, por ejemplo, a partir de una entrada de datos inexpresiva [3].
En general, posiblemente se pueda decir que los científicos suelen tener un enorme aprecio por la música, incluso si no llegan a los extremos del físico V. F. Weisskopf, que decía que cuando la vida se pone difícil hay dos cosas que hacen que merezca la pena seguir viviéndola: Mozart y la mecánica cuántica. En la música hay claramente algo matemático, abstracto y racional, además de su capacidad para provocar un impacto emocional y sensitivo en el oyente. Según Leibniz, matemático, filósofo y teórico de la música y de la percepción tonal, el placer de la música es el placer de contar sin darte cuenta de que estás contando. Y para Tim Gowers, matemático célebre, ganador de la medalla Fields (el "Nobel de Matematicas") y pianista de Jazz, las matemáticas y la música manejan estructuras abstractas, así que si eres bueno en una no es extraño que seas bueno en la otra. Se ha argumentado también que el pensamiento creativo es transdisciplinar y transferible de un campo a otro [4], y que habilidades útiles para un músico (formación y reconocimiento de patrones, pensamiento analógico y analítico, imaginación y sensibilidad estética, gusto por la experimentación, búsqueda de lo original y novedoso, imaginación, perfeccionismo, inconformismo, espíritu crítico) lo son también en un científico.
Mi conclusión es que lo sorprendente y difícil de entender es que cause extrañeza una banda de científicos, cuando los científicos músicos son legión. ¡Pero si incluso el bioquímico que acuñó el término "vitamina" se apellidaba Funk!
Música y zeolitas
Yo trabajo con zeolitas, materiales cristalinos microporosos con muchas aplicaciones y propiedades muy interesantes y variadas.
A través de sus poros, de tamaño similar a moléculas pequeñas, pueden difundir gases y reaccionar allí de una manera diferente a como lo harían en un espacio mayor. También se pueden separar mezclas de gases, o cambiar cationes (como el calcio del agua) por otros. Las zeolitas pueden ser ácidos sólidos que mantienes en la mano sin que te quemen. Pueden emplearse en una variedad enorme de aplicaciones, algunas tan peculiares como el acondicionamiento de campos de golf (con tecnología desarrollada por la NASA para la colonización del espacio), o la fabricación de barriles de cerveza que se enfrían solos.
Pero sus campos de aplicación más importantes tienen que ver con la catálisis (promover que una reacción química se produzca de una determinada manera y produzca un determinado compuesto y no otro), la separación o purificación de gases (por ejemplo, obtención de N2 y O2 a partir del aire sin usar bajas temperaturas) y como aditivos para detergentes (ablandando el agua, es decir, cambiando Ca2+ y Mg2+ por Na+, para que se pueda formar espuma).

Fig. 3. ITQ-7, una zeolita descubierta por el autor y su entonces estudiante de doctorado, el profesor y trompetista L. Å. Villaescusa.
Puedes pensar que es algo muy raro, y que se escribe raro [5], pero casi con seguridad tienes zeolitas cerca de ti. Por ejemplo, si en casa, en clase o en el trabajo tienes ventanas aislantes de las que tienen múltiples paneles de vidrio, o si usas detergentes de los llamados ecológicos, tienes zeolitas cerca.
Conozco a unos cuantos músicos trabajando con zeolitas, incluyendo a varios de mis alumnos de doctorado (Luis Å. Villaescusa, aprendiz de trompetista, Alex Rojas, batería en WEE, Peng Jacky Lu, cantante). Pero, aparte de eso, no veo que haya ninguna relación entre música y zeolitas, aunque en una ocasión el cantautor Ricardo Cantalapiedra, encarnado en su alter ego Rocky Bolero, me dedicó una canción cambiándole la letra: ese lunar que tienes, zeolito lindo, junto a la boca... Mi dedicación a las zeolitas y a la música parecen ser proyectos independientes, aunque es verdad que siempre quise llevar una doble vida.
La música porque sí.
Al final de aquella Noche de los Investigadores con la que abría estas páginas nos entrevistó una periodista de El Mundo, que publicó la noticia en su versión digital al día siguiente bajo el titular "La música por si acaso" [6]. ¿Por si acaso? Bueno, podría tener sentido, estábamos a finales de 2010, la crisis había llegado para quedarse e iba a golpear muy fuertemente a la ciencia en España, y al CSIC en particular, de una manera muy cobarde, cebándose en sus eslabones más débiles. De los 7 músicos que tocaron aquel día yo era el único con un puesto fijo. La inmensa mayoría de los cerca de 20 músicos-científicos, físicos y químicos, experimentales y teóricos, que pasaron por W.E.E. están hoy fuera del CSIC, fuera de España y de sus países de origen. Una auténtica diáspora científica. Solo tenemos un puesto estable en el CSIC los que ya lo teníamos antes de la crisis (Arturo, Álvaro B. y yo). Pero casi todos siguen, que yo sepa, en mayor o menor grado, en la ciencia y en la música, y no creo que ninguno estuviera en W.E.E. buscando una alternativa a nada. Era y sigue siendo la música y la ciencia porque sí, por vocación, porque es divertido y emocionante. Por último aclaro que, aunque se me ocurrió una mínima parte de una estrategia para sintetizar cintas de Moebius de grafeno, finalmente solo las "sinteticé" de papel.
Referencias y Notas:
[4] R. S. Root-Bernstein, Leonardo, Vol. 34, No. 1, pp. 63–68, 2001.
[5] "Zeolita" viene de dos palabras griegas, ζέω (zeo, hervir) y λίθος (litos, piedra): "piedra que hierve". Por eso se escribe con zeta (zeo).
Miguel A. Camblor
Doctor en Ciencias Químicas; Profesor Investigación, Instituto de Ciencia de Materiales de Madrid, CSIC
La verdad es que, desde muy pequeño, he querido ser médico. Sin embargo, cuando me llegó el momento de entrar en la Universidad me di cuenta que no era el único que había pensado en lo mismo. Era como si todo el mundo quisiese estudiar medicina y las distintas facultades, repartidas por todo el territorio español, se encontraban desbordadas de solicitudes de entrada. Conclusión, te exigían una nota media bastante alta para poder acceder a sus aulas. Yo no lo logré y opté por la facultad de Biológicas, pues otra de mis inquietudes era la biología marina, con el firme propósito de hacer la especialidad en Oceanografía. Al acabar el tercer curso, cuando debía decidirme por la especialidad para continuar la carrera, mis predilecciones habían cambiado. Esto fue debido, entre otras cosas, por la lectura del libro de Paul De Kruif titulado "Cazadores de Microbios", que me metió el gusanillo de la investigación en biomedicina, por lo que decidí enrolarme en la especialidad de Bioquímica y Biología Molecular. Dicho y hecho. Cuando acabé la carrera quise hacer un doctorado que acabaría defenestrándome, tarde o temprano a la investigación biológica. Pero (siempre tiene que haber algún pero…), había olvidado algo importante en los años en que me movía. No había hecho el servicio militar, dado que lo había ido retrasando mediante permisos de estudio, y ahora la Patria me lo demandaba. Por sorteo, entré en el cuerpo de Ingenieros donde pasé trece meses de mi vida sirviendo en una compañía de transmisiones, de acción inmediata, en la III Región Militar, comandada por aquel entonces por el General Jaime Milans del Bosch y Ussía. Controvertido militar que se haría famoso por su participación en el intento de golpe de Estado de 1981. Por cierto, dicho sarao aconteció solamente un mes después de haberme licenciado del ejército, por lo que me libré de que me sacaran a las calles de la ciudad de Valencia, armado hasta los dientes, sin saber qué era lo que estaba pasando esa fatídica noche del 23 de febrero, cosa que les ocurrió a mis antiguos compañeros de cuartel.
Estabilizada la democracia me di cuenta que nadie iba a venir a casa a ofrecerme hacer la tesis doctoral en un tema de rabiosa actualidad, así que me tiré a la calle a buscar un laboratorio de mi interés que me aceptara. La cosa no resultó fácil, dado que, si lograba que algún IP se interesara por mí, había que hacer una memoria de trabajo y solicitar una beca, cosa altamente competitiva y de difícil obtención. Puedo asegurar que me recorrí muchos laboratorios, tanto de la universidad como del CSIC, sin conseguir realmente nada. Por lo general muy buenas palabras y recomendaciones de unos colegas a otros y casi nada más.

Ahora sería imposible, pero entonces se podía hacer algo que no estaba mal visto. Me refiero a poder trabajar en un laboratorio sin financiación. Es más, era una cosa común, donde los becarios, sin beca, poco menos que hacíamos cola para que el jefe nos fuera presentando, por riguroso orden de incorporación, a concursar por una beca que nos llevase, en última instancia, a obtener el tan deseado título de doctor. Pero como todos los que conocéis este mundillo sabéis, la cosa no acaba ahí. Después vendrán varios años de postdoc en el extranjero y las duras oposiciones para lograr el funcionariado en alguna de las escalas científicas del CSIC o de la Universidad.
Sea como fuere, y haciendo uso de valiosas recomendaciones, entré a trabajar en un laboratorio del Instituto de Edafología (estudio de suelos) del CSIC. Allí se trabajaba en toxicología de plaguicidas y yo empecé a estudiar cómo se acumulaban distintos tóxicos en las aceitunas. Trabajo más químico que otra cosa, pues hacíamos extracciones con solventes orgánicos, cromatografía de gases, etc. Nada que me entusiasmase en absoluto, pero dado a como estaba el patio aguanté allí hasta vislumbrar alternativas mejores. Dado que no cobraba nada de dinero, aleccionado por un amigo, me apunté en una asociación de extras de cine, donde nos llamaban de vez en cuando para hacer figuración en películas. Eso me proporcionó un poco de dinero para mis gastos. Aquello era otro mundo. Por supuesto muy distinto al mundo académico por el que estaba luchando para hacerme un hueco, pero que sin duda me reportó algunas satisfacciones y, de hecho, me catapultó, sin darme cuenta, a lo que finalmente me dedicaría toda la vida, la Neurociencia. ¿Cómo pudo ser esto? En 1982, José María Forqué dirige una serie para TVE sobre la biografía de Santiago Ramón y Cajal, y fui llamado en varias ocasiones para hacer distintas escenas. Esa serie fue el acercamiento de Cajal a la población de a pie y he de confesar que para mí también fue así, pues yo en aquella época sabía muy poquito de Cajal. La lectura de sus "Reglas y consejos para la investigación biológica" me fascinó. Pero la puntilla me la dio conocer por aquellos días a la que con el tiempo se convertiría en mi mujer, que trabajaba, mientras estudiaba la carrera, de ayudante del Profesor Valverde, uno de los científicos más conocidos del Instituto Cajal. De su mano entré en ese Instituto y de su mano empecé a admirar a Cajal. Introducido en la histología del sistema nervioso quedé hechizado por la belleza e idiosincrasia de las neuronas y no pude más que pedir al Profesor Valverde que me permitiese hacer la tesis doctoral con él. Cuando logre que me aceptase (no cogía a nadie y yo me convertí en su primer doctorando), dije adiós al laboratorio de toxicología del Instituto de Edafología y me instalé en el Instituto Cajal, centro que ya solo dejaría para hacer una estancia postdoctoral de tres años en los EEUU.
El Instituto Cajal supuso para mí aprender mucha neurociencia y definirme por la investigación en Neurobiología del desarrollo, lo que me hizo admirar tremendamente a Cajal, valorar sus investigaciones, sus descubrimientos y desear ser como él. Cajal vivió en un ambiente hostil para le investigación en la España de final del siglo XIX. Sin embargo, hizo descubrimientos seminales que sentaron las bases de las Neurociencias modernas al ser capaz de elaborar y enunciar la Teoría Neuronal. Demostró inequívocamente que el sistema nervioso está formado por células individuales, neuronas (término acuñado posteriormente por Waldeyer), que se conectan entre sí por contigüidad y no por continuidad como se pensaba en aquella época. Dichas conexiones se realizan mediante pequeños contactos, hoy denominados sinapsis (término acuñado por Sherrington). La célula nerviosa se compone de tres partes diferenciadas y especializadas, el cuerpo celular o soma, el axón y las prolongaciones dendríticas (denominados inicialmente por Deiters como cilindro-eje y procesos protoplásmicos, respectivamente). Los estudios anatómicos de Cajal siempre estuvieron enfocados a un contexto funcional. En este sentido, una de sus hipótesis más destacadas fue la Ley de la polarización dinámica, que pone de manifiesto que las neuronas están polarizadas funcionalmente, de tal manera que los impulsos eléctricos son captados por las dendritas y se propagan desde estas estructuras al cuerpo celular, donde se procesan y son conducidos y liberados por el axón. El genio de Cajal era tal que siempre vio a las neuronas como unidades que procesan información, que hacen conexiones y se organizan en redes dinámicas (circuitos) para llevar a cabo distintas funciones.
Sin lugar a dudas, la Teoría Neuronal constituye la base para entender la organización del sistema nervioso. Cajal, además de estudiar y describir todas las estructuras del sistema nervioso central y periférico, en distintas especies animales, incluido el hombre, aportó pequeños detalles anatómicos que nos explican la funcionalidad y fisiología de este sistema. Así, describe unos apéndices sésiles sobre las dendritas de las células piramidales (células de proyección), a los que denomina espinas dendríticas. Estos aparatos aumentan enormemente la superficie de las dendritas y están directamente implicadas en las comunicaciones que se realizan entre las células. Hoy en día sabemos que sobre las espinas dendríticas se realizan las sinapsis excitatorias, realizándose los contactos inhibitorios sobre los segmentos desnudos de las dendritas y sobre el cuerpo celular. Así mismo, describe el cono de crecimiento, una estructura con forma de cono que se encuentra en el extremo de los procesos celulares en crecimiento. Lo describe como una estructura cambiante que va sondeando el camino y tomando decisiones por donde deben crecer las fibras nerviosas. Esto lo hacen en virtud a la atracción que inducen unas moléculas difusibles secretadas por células o estructuras próximas que crean gradientes químicos, y esto no es ni más ni menos que el fenómeno de la quimiotaxis.
A parte de sus estudios sobre histología general y anatomía patológica, los últimos aspectos que aborda sobre el sistema nervioso es el estudio de la degeneración del mismo y su posible regeneración.
Cajal recibe muchos premios y distinciones a lo largo de su vida; entre las más importantes se encuentran: el Premio Moscú (1900), la Medalla de Oro de Helmholtz (1905) y el Premio Nobel en Medicina o Fisiología (1906).
La verdad, no pude encontrar mejor maestro, aquel año de 1982, que Cajal, para querer ser como él y dedicar mi vida al estudio del sistema nervioso.
Juan A. de Carlos Segovia
Doctor en Neurobiología; Investigador Científico, Instituto Cajal CSIC
Aún recuerdo cuando en una clase del primer año de licenciatura, un decidido profesor de geología hacía girar un taco de madera que sostenía entre dos dedos de su mano.

Fig. 1. Octaedro
El sólido que mostraba estaba tallado en forma de octaedro (Fig. 1), y dándole vueltas trataba inútilmente de que entendiéramos el significado de frases parecidas a "…y esta es la cara uno, uno, cero…". Un compañero, más perspicaz que yo, insinuó que debía de tratarse de alguna explicación sobre algo que parecía estar relacionado con los cristales. Pero mirando de reojo a las desvencijadas cristaleras de las ventanas de la Facultad nos preguntamos ¿de qué cristales estaría hablando? Finalmente pudimos deducir que todo aquello probablemente estaría relacionado con los minerales pero, en cualquier caso, el asunto pasó al sueño de los justos durante el resto de la licenciatura. Curiosidades del destino… pasados aquellos años, aquel joven estudiante de química acabó el resto de su vida conquistado, no por los tacos de madera o por las frases enigmáticas, sino por algo tan atractivo y potente, tan antiguo y tan moderno, como es la ciencia que estudia los cristales, la Cristalografía. Veamos pues de qué cristales hablaba aquel profesor, cuál es la magia e importancia que encierran, y dónde se pueden encontrar, ya que precisamente es en las "cristalerías" en donde no venden cristales.
¿Qué son los cristales, qué es la cristalografía y para qué sirve?
La cristalografía es la ciencia que estudia los cristales. Hoy sabemos que los cristales están hechos de átomos, moléculas y/o iones que se apilan ordenadamente, y con cierta simetría, en las tres direcciones del espacio, tal y como en ocasiones se ven las piezas de fruta en un mercado (Fig. 2).
Estos modos de empaquetamiento y repetición internos provocan en los cristales diferentes tipos de hábitos (formas externas), que en el caso de los minerales, y desde hace miles de años, llamaron la atención por sus propiedades y colores. Muy probablemente esta aclaración ya le habrá servido al lector para darse cuenta de que, cuando llamamos "cristales" a los materiales que cierran nuestras ventanas, cometemos un error.
Esta perversión lingüística hay buscarla en el hecho de que en el siglo I d.C. los antiguos romanos usaban grandes cristales del mineral Lapis specularis (el nombre en latín para los cristales de yeso trasparente), exfoliados en láminas, para cerrar las ventanas de sus invernaderos.
Y es que esta forma deshidratada del sulfato de calcio, debido a su transparencia, gran tamaño y planaridad, se extraía en grandes cantidades de las minas de Segóbriga (España). Los mal llamados cristales de las ventanas de hoy son realmente vidrios, materiales cuyos átomos apenas muestran orden de apilamiento en su interior.

Fig. 2. El apilamiento ordenado de objetos (naranjas, átomos, o moléculas) genera formas externas llamativas.
Los cristales representan la forma más estable de la materia. Los encontramos en toda la Naturaleza, desde los minerales hasta en la nieve o los huesos, o los usamos en la memoria de nuestros teléfonos, el fuselaje de los aviones, el chocolate, los fármacos, y en general en casi cualquier tipo de materia. Con las primeras herramientas que se desarrollaron durante el siglo XX alrededor de esta ciencia, la cristalografía pasó del estudio de la morfología y simetría de los cristales a ser la herramienta fundamental para averiguar la estructura intima de la materia, sea ésta viva o inanimada. Conocer la estructura interna de la materia significa averiguar las posiciones de todos los átomos que la forman y determinar sus modos de unión, generalmente en forma de agrupaciones atómicas que conocemos con el nombre de moléculas.

Fig. 3. Sólo después de que por medio de la cristalografía se pudiera determinar la estructura molecular de la penicilina (1945), los químicos pudieron abordar su síntesis, consiguiendo así salvar millones de vidas.
La estructura tridimensional, atómica y molecular, de la materia genera un conocimiento muy valioso que es utilizado por químicos, físicos, biólogos, bioquímicos y muchos otros investigadores, pues esta información permite no sólo comprender las propiedades de la materia, sino también modificarlas para nuestro beneficio (Fig. 3).
¿Y cómo se consigue todo esto? ¿Hay una luz capaz de dejarnos ver el interior de los cristales?
Asomarse al interior de un cristal no deja de ser una experiencia parecida a la del astrofísico que, por primera vez, ve una galaxia que nadie vio antes. Y aunque el mundo que explora el cristalógrafo no mire hacia el cielo, y sea de dimensiones cien millones de veces más pequeñas que un garbanzo, ¡es realmente mágico! En él flotan los átomos, como si de astros se tratara, unidos por fuerzas de muy diversa naturaleza, dando lugar a empaquetamientos y formas caprichosas que llamamos moléculas, a veces giradas unas respecto de otras, y en ocasiones como asomadas a un espejo. Pero la magia no reside exclusivamente en la observación de las formas de este microcosmos, sino también en el camino que conduce a su descubrimiento.
Salvo en el caso de los minerales, el trabajo del cristalógrafo comienza con la obtención de cristales, un proceso no siempre sencillo, pero especialmente delicado en el caso de la materia animada, como las proteínas y los enzimas, pues estas sustancias generan cristales que pueden contener hasta un 80% de agua en su interior. Es realmente sorprendente comprobar que tras experimentar con diferentes condiciones, como por ejemplo añadiendo determinadas sales, o cambiando el pH, una gota de una disolución de una macromolécula se llena de diminutos cristales, con caras y aristas perfectamente delimitadas, aunque extremadamente frágiles. Pero lo más llamativo comienza a partir de aquí, pues es necesario disponer de algún artilugio capaz de escudriñar el interior de uno de esos cristales. El proceso que nos permite dicha incursión fue descubierto en 1912, hace algo más de cien años, por un científico alemán, Max von Laue, que tuvo la brillante idea de iluminar un cristal de sulfato de cobre con una luz cuya naturaleza nadie conocía, los rayos X, descubiertos años antes (1895) por otro alemán, Wilhelm Conrad Röntgen. El resultado de aquel experimento mató dos pájaros de un tiro; puso de manifiesto que los rayos X eran de naturaleza ondulatoria (como lo es la luz visible) y que dichas ondas eran capaces de dispersarse de modo muy especial a través de los cristales, lo cual demostraba que éstos constituían un medio ordenado que hacía las veces de rendijas dispersoras. El orden interno de los cristales provoca que la dispersión de los rayos X sea cooperativa y este fenómeno, conocido con el nombre de difracción, da lugar a cientos, miles, y cientos de miles de ennegrecimientos en una placa fotográfica.

Fig. 4. Descubrir la estructura de los cristales es como resolver un puzle con piezas que no contienen dibujos.
Pero una vez obtenido el patrón de difracción, es cuando debe de producirse un supuesto milagro, pues el cristalógrafo necesita virtualmente "recorrer el camino inverso" que viajan los rayos X cuando van desde el cristal hasta la placa fotográfica (el detector). El grave problema que se plantea es que retroceder ese camino es como tratar de resolver un puzle con cientos, miles y cientos de miles de piezas que no disponen de dibujo y apenas de perfil (Fig. 4). Los haces de rayos X difractados (ondas) llegan al detector, unos respecto a otros, en un estado de vibración que no podemos medir experimentalmente. Son las matemáticas a través de la denominada "transformada de Fourier" la que, mediante ingeniosos procedimientos, nos permite finalmente llegar al punto de partida, al interior del cristal, y descubrir todos los detalles de ese mundo microscópico en donde "viven" los átomos y las moléculas.

Fig. 5. Estructura molecular de LytC, una enzima de la bacteria Streptococcus pneumoniae.
De este modo, la cristalografía, con la ayuda de los rayos X, resulta ser como una "lupa mágica" capaz de desvelar el interior de la materia. ¡Pero tampoco concluye aquí la tarea del cristalógrafo! Al margen de la satisfacción que supone haber desvelado la forma y dimensiones de las moléculas, o del ordenamiento interno de un cristal, el último desafío consiste no sólo en analizar esas estructuras, sino en comprenderlas y sugerir pequeños cambios en dichas estructuras para mejorar sus propiedades físicas y químicas, incluyendo su actividad biológica. Gracias al ingente conocimiento que nos proporciona la cristalografía (que hasta la fecha ya ha generado hasta 29 Laureados Nobel) somos capaces de producir materiales con propiedades prediseñadas, desde catalizadores para una reacción química de interés industrial, hasta pasta de dientes, placas de vitrocerámica, materiales de gran dureza para uso quirúrgico, o determinados componentes de los aviones, por poner algunos ejemplos. Más aún, la cristalografía nos proporcionó los secretos del ADN, el llamado código genético. Podemos aumentar la resistencia de las plantas frente al deterioro medioambiental y diseñamos fármacos capaces de interaccionar con las proteínas, las máquinas de la vida. Somos capaces de comprender, modificar o inhibir enzimas implicados en procesos fundamentales de la vida y muy importantes para los mecanismos de señalización que ocurren en el interior de nuestras células, como el cáncer. También gracias a la cristalografía hemos conocido la estructura del ribosoma, la mayor fábrica de proteínas de nuestras células, y podemos entender el funcionamiento de los antibióticos y modificar su estructura molecular para mejorar su eficacia. De la estructura de enzimas producidas por ciertos virus (Fig. 5), hemos aprendido cómo combatir bacterias con alta resistencia a antibióticos, y ya somos capaces de desentrañar las sutiles maquinarias de defensa que han desarrollado estos gérmenes, con lo que no es un sueño pensar que podremos combatirlos con herramientas alternativas a los antibióticos.
El lector interesado debería consultar el portal dedicado a la enseñanza de esta disciplina [1], y adicionalmente, si le resulta más agradable el contacto con el papel, le remitimos a un ensayo reciente [2].
A modo de conclusión
La cristalografía es probablemente una de las disciplinas científicas más transversal o pluridisciplinar, amén de útil para la ciencia actual. Necesita de las matemáticas y de la física para comprender la naturaleza repetitiva de los cristales y para interpretar el fenómeno de la difracción de los rayos X, y al demostrar la indiscutible relación existente entre la estructura tridimensional de los materiales y sus propiedades, la cristalografía contribuye decisivamente al avance de la química, la física aplicada, la ciencia de materiales, la geología, la bioquímica, la biología molecular y la biomedicina. ¡Apúntate!
Referencias:
[1] F.H. Cano, M. Martínez-Ripoll, "Cristalografía-Crystallography", Web para la enseñanza de la Cristalografía,
[2] M. Martínez-Ripoll, J.A. Hermoso, A. Albert (coord.), "A través del cristal. Cómo la cristalografía ha cambiado la visión del mundo", CSIC-Catarata (2014), 196 págs., ISBN: 978-84-00-09800-1.
Martín Martínez-Ripoll
Doctor en Ciencias Químicas; Profesor de Investigación Ad Honorem, Instituto de Química-Física "Rocasolano", CSIC
Seguramente sea la primera vez que leas la palabra «dendroecología», a pesar de la importancia de esta rama de la Ecología fundamental para comprender mejor nuestro pasado, presente y futuro. Está formada por el prefijo dendro- (del griego dendron), que significa «árbol» y por la raíz -ecología, también procedente del griego, que hace referencia a «la ciencia que estudia los seres vivos como habitantes de un medio, así como las relaciones que mantienen entre sí y con el medio donde habitan». Juntándolo todo tenemos que la dendroecología es la ciencia que estudia los árboles y las relaciones que estos mantienen con el ambiente que les rodea. Yo, como dendroecóloga, me dedico a estudiar cómo funcionan los árboles en su entorno para poder predecir cómo pueden cambiar nuestros bosques en los próximos años. La gente piensa que voy al campo a abrazar árboles y no van muy desencaminados… Pero, además de abrazarlos, los estudio, los mido y ¡hasta los pincho!
¿Por qué abrazar árboles?
Porque los árboles, como organismos capaces de fabricar su propio alimento, nos aportan el oxígeno que respiramos. Gracias a la fotosíntesis las plantas absorben dióxido de carbono (CO2) de la atmósfera y liberan oxígeno (O2). Así que la importancia de las plantas es evidente: sin ellas no existirían los organismos que necesitan respirar oxígeno, como los seres humanos. Pero además tienen beneficios incontables: dan cobijo a los animales, absorben contaminantes, favorecen las características del suelo, evitan la erosión… En el caso particular de las plantas leñosas (árboles y arbustos) su importancia radica en que son perennes, es decir, que no mueren tras la estación de crecimiento y reproducción. Esto implica que la cantidad de CO2 ―causante del calentamiento global― que pueden captar es muy grande y éste, en lugar de ser liberado de nuevo al ambiente, queda almacenado en los bosques, retenido en la madera, raíces, ramas y hojas durante mucho tiempo.

Fig. 1. Esquema en el que se muestra la extracción de un testigo de madera de una conífera (a) para el posterior estudio de los anillos de crecimiento (b), que nos proporcionan gran cantidad de información ambiental, histórica y climática si somos capaces de interpretarla (c).
Todos estos beneficios hacen necesario que cuidemos los árboles, abrazándolos o no, pero sobre todo conservando y protegiendo los ecosistemas donde viven, que es uno de los objetivos de los dendroecólogos.
¿Por qué pinchar los árboles?
Una de las características más increíbles de los árboles es su longevidad; son seres vivos capaces de vivir muchos años. Muchos más que los humanos. Por ejemplo: recientemente he estado trabajando con pinos de alta montaña del Pirineo que tenían hasta 800 años, es decir, que germinaron en el siglo xiii. Incluso se han encontrado en Estados Unidos árboles con ¡más de 5000 años! Dado que los árboles son capaces de almacenar información (ambiental, histórica y climática) en cada año de crecimiento, el encontrar un árbol viejo para mí es como para un historiador descubrir un archivo muy antiguo repleto de información. Los dendroecólogos somos capaces de entender esa información almacenada en la madera durante cientos de años. ¿Cómo? Pues muy fácil: gracias a que los árboles no sólo crecen en altura, sino también en grosor y, al hacerlo, forman un anillo de madera distinto cada año. Es como si nosotros engordáramos un poco cada año y con ello dejásemos una marca en nuestro cuerpo. Sin embargo, a diferencia de los humanos que dejamos de crecer (¡en tamaño!) tras la adolescencia, los árboles forman anillos desde los primeros años de vida hasta que son viejos y mueren. Para poder acceder a esa información, los dendroecólogos «pinchamos los árboles» con una barrena y de esa forma obtenemos un testigo de madera o core en inglés (Fig. 1a). Estos cores son unos cilindros extraídos del tronco (Fig. 1b), desde el centro del árbol (médula) hasta la corteza, y en los cuales se ven todos los anillos de crecimiento. Un dendroecólogo tiene la capacidad de estudiar toda la información que nos proporciona cada anillo (Fig. 1c).
¿Por qué se forman los anillos de crecimiento en la madera?
No todas las plantas forman anillos de crecimiento, solo las leñosas: árboles y arbustos. Y no todos los árboles y arbustos forman anillos cada año tampoco, ya que la formación de un anillo implica que haya un parón en el crecimiento por la estacionalidad del clima. Por lo tanto, en las zonas del planeta donde las condiciones climáticas varían poco durante el año, como en las zonas tropicales bajas, no hay un parón del crecimiento en los árboles y no somos capaces de ver la diferencia entre años. Sin embargo, en ecosistemas templados y mediterráneos, como los que encontramos en la Península Ibérica, las estaciones con condiciones climáticas muy distintas van a dar lugar a la formación de anillos (Fig. 2). Así, el árbol empieza a crecer en la estación favorable (primavera), cuando las temperaturas templadas y la lluvia permiten una activación de los tejidos vegetales del árbol tras el invierno. El árbol sigue creciendo hasta que el calor intenso y la falta de agua impiden la formación de nuevas células (finales de verano y principios de otoño).

Fig. 2. Testigo de madera o core en el que pueden verse: el centro del árbol (médula), la corteza (parte más externa) y los anillos de crecimiento. Se muestra el detalle de uno de los anillos, correspondiente al año 1970, en el que se ven las células (vasos conductores de savia) formadas al principio de la primavera y aquellas formadas al final del verano, cuando termina la estación de crecimiento.
Es en esa época cuando el árbol, en lugar de formar más células conductoras de savia, lo que hace es usar más carbono para hacer las paredes celulares más gruesas (Fig. 2). Por ello vemos una zona más oscura (células de paredes engrosadas) que corresponde al parón de crecimiento. Finalmente, el árbol pasa por una fase en la que se mantiene «dormido», es decir, vivo pero sin crecer por limitaciones de frío (invierno). Gracias a estas fases tan marcadas, al estudiar los anillos podemos conocer cómo ha sido el funcionamiento de los árboles a lo largo del año y compararlo con los distintos años durante toda su vida.
¿Por qué es interesante entender el crecimiento de un árbol?
Existen principalmente tres características que definen el funcionamiento de un árbol: su crecimiento, su reproducción y su supervivencia. Así, es imprescindible el estudio de esas tres características para comprender cómo funcionan los árboles y los bosques en los que habitan. Y la dendroecología está destinada a entender el crecimiento fundamentalmente, aunque éste está muy relacionado con la reproducción y con la supervivencia. Por ejemplo, la mayoría de los árboles necesitan alcanzar un tamaño mínimo para poder reproducirse y el hecho de que un árbol deje de crecer puede dar lugar a la muerte del mismo si esta parada del crecimiento se prolonga en el tiempo. Hay numerosos factores que pueden afectar al crecimiento, como por ejemplo las interacciones con otros individuos de su misma o de distintas especies. Estas interacciones pueden ser negativas, como la competencia con otros individuos por el agua cuando hay sequías, lo que da lugar a una disminución del crecimiento. Por otro lado también existen las interacciones positivas, como cuando unos árboles mejoran las condiciones del medio ambiente donde viven y de esta forma favorecen el crecimiento de otros árboles cercanos. Sin embargo, los factores más importantes que afectan al crecimiento son los climáticos. En ocasiones los árboles pueden estar prácticamente sin crecer durante varios años cuando están muy estresados sin que esto suponga que estén muertos. Porque sí, ¡los árboles también se estresan!
¿Por qué se estresan los árboles?
El cambio climático ha producido alteraciones de la temperatura y las precipitaciones durante las últimas décadas debido al aumento en los gases de efecto invernadero en la atmósfera. Uno de estos gases es el dióxido de carbono (CO2) que está directamente relacionado con el calentamiento global. En países de clima mediterráneo, por ejemplo, se han registrado aumentos de temperatura de hasta 1,3ºC desde la Revolución Industrial, cuando empezaron a emitirse estos gases a la atmósfera. Pero además han aumentado recientemente las condiciones extremas de sequía y hay mayor riesgo de incendios y lluvias torrenciales. Como hemos visto antes el crecimiento de los árboles está muy relacionado con el clima, por lo que parece evidente que va a haber una serie de consecuencias de estos cambios climáticos en el funcionamiento de los árboles y, por tanto, en los bosques. Cabría pensar que estas consecuencias podrían llegar a ser beneficiosas: si hay más CO2 en la atmósfera, los árboles deberían crecer más ya que son organismos que se alimentan del dióxido de carbono. Sin embargo, esto normalmente no ocurre porque el aumento de CO2 está asociado a la sequía y el calentamiento global y estos son factores que producen estrés en las plantas. Dicho estrés da lugar al cierre de los estomas (poros que hay en las hojas por donde entran y salen moléculas de CO2 y agua) y como consecuencia no pueden aprovechar esa mayor cantidad de alimento. Si lo comparamos con los humanos, sería como si nos encontráramos ante una mesa llena de comida pero tuviéramos la boca cerrada y no pudiésemos comer nada. Los dendroecólogos podemos conocer cuánto carbono han consumido y utilizado los árboles cada año, lo cual nos da información de su nivel de estrés. Además, los árboles sufren enfermedades que, como las de los humanos, tienen relación con diferentes organismos que se aprovechan de ellos para sobrevivir. Un claro ejemplo es el caso del muérdago, una planta hemiparásita que le roba el alimento a los árboles; o la procesionaria, insecto cuyas larvas se alimentan de las hojas. Pues bien, estas enfermedades y otras, que se están extendiendo en mayor medida en los últimos años, pueden ser detectadas históricamente en los anillos de crecimiento.
Dado que el cambio climático y la alteración de la atmósfera pueden perjudicar el funcionamiento de una o varias especies leñosas, se esperan cambios en la composición de nuestros paisajes boscosos como los conocemos en la actualidad. Por tanto, es necesario que nos esforcemos en limitar las emisiones de gases de efecto invernadero a la atmósfera y en conservar los bosques impidiendo los incendios provocados, conservando la biodiversidad y evitando la mortalidad de los árboles. Para ello es importante conocer qué árboles están estresados, las causas y consecuencias, así como conocer la forma en la que actúan ante ese estrés. Así, el papel de los dendroecólogos es fundamental para predecir qué va a pasar en el futuro con nuestros bosques y minimizar las consecuencias del cambio climático en la medida de lo posible. ¡Os animo a cuidar nuestros bosques, abrazar nuestros árboles y estudiarlos para comprenderlos mejor!
Elena Granda
Doctora en Biología; Investigadora Postdoctoral, Instituto Pirenaico de Ecología, IPE-CSIC
Me hubiera gustado comenzar este texto con alguna anécdota entrañable de mi infancia que explicara de manera atractiva por qué me he dedicado laboralmente a la ecología evolutiva. Y no es que no las haya, que las hay y muchas, sino que realmente estoy convencida de que han sido las circunstancias las que, a fin de cuentas, han hecho de mí una bióloga interesada en el estudio de la ecología y la evolución de los seres vivos. Estudié biología, porque desde siempre me han gustado los animales. Pero han sido buenos profesores de la Universidad Complutense de Madrid los que además de enseñarme los conceptos académicos, me enseñaron a disfrutar con el trabajo de campo rutinario y la toma de datos. Fui afortunada y obtuve una beca para hacer mi tesis doctoral en el Museo Nacional de Ciencias Naturales, y aunque me gustaba mucho más el campo que el laboratorio, fue mi director de tesis realmente el que me ofreció trabajar con las adaptaciones ecológicas de un reptil subterráneo. Mis amigos y compañeros del departamento de Ecología Evolutiva donde disfruto de mi plaza de Investigadora, y demás colegas que posteriormente he ido conociendo en otros centros de investigación, congresos y reuniones han ido formándome y enseñándome a lo largo de mi carrera científica. Incluso, los editores y revisores de mis artículos científicos, con sus críticas constructivas, o no tanto, han influido en la calidad de mi currículum. Mi hija, que siendo como es, me ha dejado conciliar sin problemas mi vida laboral y personal. Y por supuesto Darwin y su teoría de la Evolución. Estas "circunstancias" que decía al comienzo, son las que han dirigido, a fin de cuentas, mi carrera investigadora. Sin todos ellos, la cosa nunca hubiera sido de la misma manera. Seguro.
¿Qué es la Ecología Evolutiva?
Cuando a cualquiera le preguntan qué es la ecología es muy fácil que sepa responder. La ecología es la parte de la biología que estudia las relaciones de los seres vivos entre sí y con el medio en el que viven. Es una definición que hemos escuchado o leído en libros de texto muchísimas veces. Pero, ¿qué es la ecología evolutiva?

Fig. 1. Fotografía de Charles Darwin y de su libro On the Origin of Species, publicado el 24 de noviembre de 1859 donde se postula la teoría de la evolución por selección natural. Créditos: De J. Cameron - Desconocido; Dominio público
La ecología evolutiva estudia las causas y las consecuencias de la diversidad de la vida. Analiza la diversidad de las características morfológicas, demográficas y de comportamiento en los organismos y el grado de adaptación de estos al medio ambiente, incluyendo su contexto social, e identifica las presiones selectivas que influyen o han influido en la evolución de las características que se observan en ese organismo en la actualidad. Existen, como vemos, 2 conceptos evolutivos que convierten a la ecología en ecología evolutiva. La selección natural y la adaptación. En la Teoría de la Evolución, Darwin afirmaba que la selección natural es el mecanismo, que ha hecho cambiar, evolucionar, a los organismos hasta su estado actual. El ambiente en el que viven los organismos va cambiando, y estos cambios generan problemas que los organismos deben resolver para poder crecer y reproducirse. Las soluciones a estos problemas son las adaptaciones. La adaptación, por tanto, es un proceso por el cual los organismos se adaptan a su ambiente y que afecta a su supervivencia y éxito reproductivo.
Una de las principales críticas que ha recibido más a menudo la teoría evolutiva es la idea errónea de que la evolución selecciona solamente a los individuos más fuertes y mejores de una población o de una especie. Sin embargo, esta afirmación no es cierta en ningún momento. La selección no favorece a los mejores, sino a los que mejor se adaptan a los cambios que se producen en el ambiente. La selección natural funciona por cambios ambientales y no va dirigida a ningún fin u objetivo. Es decir, la evolución no va encaminada a conseguir un resultado determinado. Así, se favorecen algunas adaptaciones en determinados momentos de la vida de un organismo, pero estas pueden ir en una dirección o en otra. Y no va encaminada a ningún fin concreto.
La ecología evolutiva es una ciencia multidisciplinar y se alimenta de otras ciencias tales como la genética, la química, la física, la geología, la geografía, etc. En nuestros trabajos de investigación utilizamos muchas herramientas matemáticas, como la estadística y también se utilizan modelos matemáticos que realicen simulaciones.
Existen diferentes niveles en los estudios de ecología evolutiva, que van desde el individuo hasta el estudio de poblaciones (individuos de una misma especie que comparten hábitat), comunidades (conjunto de poblaciones que comparten hábitat) o ecosistemas. Las principales áreas de investigación en ecología evolutiva, son la ecología del comportamiento animal, la evolución de las historias de vida, la selección sexual y el cuidado parental, las estrategias reproductivas, la ecología y evolución del parasitismo, la comunicación animal, y la biología de la conservación.
La ecología evolutiva es considerada por algunos una ciencia básica. Es decir, que la utilidad de sus estudios sería únicamente el aumento del conocimiento científico sobre un tema o una especie determinada. Sin embargo, la ecología evolutiva es también una ciencia aplicada, ya que es útil para intentar combatir algunos de los problemas de nuestra sociedad actual, como son la pérdida de hábitats, la conservación de las especies en peligro de extinción, el cambio climático, la propagación de plagas o enfermedades. El objetivo principal de los estudios ecológicos es proporcionar los conocimientos científicos necesarios para colaborar en la gestión y conservación de la biodiversidad.
Algunas cosas que investigo: Señalización Múltiple en reptiles
Mis investigaciones en ecología evolutiva se han basado fundamentalmente en los temas de selección sexual y comunicación animal.

Fig. 2. Macho de lagarto verdinegro (Lacerta schreiberi) en la sierra de Guadarrama con la coloración azulada en la cabeza típica de la época reproductiva.
Me interesa especialmente conocer cómo los animales son capaces de comunicar a otros individuos de su misma especie o de otra, distintos aspectos tales como su estado reproductor, su salud, su estatus de dominancia, y cómo estas señales, especialmente las señales visuales y químicas, se mantienen evolutivamente. Me gustaría ilustrarlo con dos ejemplos de utilización de señales múltiples, visuales y químicas en 2 especies de reptiles con los que he trabajado frecuentemente.
Muchos animales producen señales sexuales diferentes o múltiples, incluso en distintos canales sensoriales (señales sexuales visuales o químicas a la vez).

Fig. 3. Pareja de lagartijas carpetanas (Iberolacerta cyreni) en la sierra de Guadarrama. El macho, de coloración más verdosa, está cortejando a la hembra para intentar conseguir una cópula
Nos preguntábamos por qué existe esta señalización múltiple y su función. En el caso del lagarto verdinegro (Lacerta schreiberi), los machos adultos tienen una coloración verde en el dorso, amarilla en el vientre y azul en la cabeza. Al analizar estos colores con un espectrofotómetro, encontramos que los machos más dominantes tienen los colores azules y verdes más brillantes. Estas coloraciones sirven, por tanto, para señalar el estatus de dominancia a otros machos. Sin embargo, los machos con mejor estado de salud tienen un color ventral amarillo más brillante, de manera que esta coloración sirve para señalar a las hembras la buena calidad genética de los machos. Estas señales visuales múltiples revelan diferentes mensajes dependiendo de si el receptor es macho o hembra.
Los machos de la lagartija carpetana (Iberolacerta cyreni) utilizan las secreciones de sus poros femorales como señales químicas múltiples. Analizando la composición química de estas secreciones mediante cromatografía de gases, encontramos que los machos con mayor tamaño corporal y más dominantes tienen también más colesterol en sus secreciones.

Fig. 4. Mi hija Ana y yo haciendo "trabajo de campo" en Kenia.
Este compuesto, sirve, por tanto, para señalar el estatus de dominancia a otros machos. Por otro lado, los machos con mejor estado de salud y mejor condición corporal tienen mayores cantidades de provitamina D y de ácido oleico en sus secreciones y son más atractivos para las hembras. Esta información puede ser utilizada por las hembras para escoger pareja. Al igual que la coloración, las señales químicas múltiples revelan diferentes mensajes según el sexo del receptor. El desarrollo de estas señales, basado en diferentes mecanismos morfológicos y fisiológicos y compromisos, permite que sean señales fiables y honestas que son utilizadas para tomar decisiones relacionadas con la reproducción.
Quedan muchas cosas por hacer. Muchas hipótesis que comprobar, miles de experimentos que realizar, y muchos artículos por escribir. ¿Te apetece?
"No es la más fuerte de las especies la que sobrevive y tampoco la más inteligente. Sobrevive aquella que más se adapta al cambio". Charles Darwin.
María del Pilar López Martínez
Doctora en Ciencias Biológicas
Investigadora Científica del CSIC. Museo Nacional de Ciencias Naturales; Editora de la revista e-VOLUCION de la Sociedad Española de Biología Evolutiva (www.sesbe.org)
Aunque hablaré mucho de ciencia, la finalidad de esta historia es mostrar la belleza que encierra el proceso de aprendizaje y mutación que sufrimos al iniciarnos en la investigación, en particular, durante la tesis doctoral: romper las barreras de lo establecido, mirar más allá del horizonte y comenzar a apreciar la incertidumbre y la libertad que conlleva un guion en blanco. Épicas batallas contra todo y contra uno mismo, en la que algunas personas luchan por ganar, otras por disfrutar y otras por inspirar o ser recordadas. Esta es mi historia.
Patatas fritas, olivas y CO2: caminando hacia la ecología
Un pensamiento recurrente en mi juventud era el futuro. No sabía muy bien cómo sería mi vida, qué estudiaría o dónde acabaría trabajando. Todas las opciones estaban abiertas. Inexperiencia, miedos e incertidumbre colaboran para nublar tu mente y dificultar la tarea de decidir. Mirando atrás, me doy cuenta de lo complicado que es descubrir lo que te gusta y elegir una carrera profesional con tan sólo 18 años. En aquel momento, mi mente inundada de inseguridades se decantaba por carreras relacionadas con la ciencia y la naturaleza. Y con el tiempo me di cuenta que esa pasión por descifrar los misterios de la vida se debía al contacto con el mundo natural -y sus frutos- durante mi infancia. Recuerdo que era un niño muy follonero y que una de las pocas cosas que me entretenía era estar con mi madre en la cocina. Algo tuve que aprender, porque un día que no estaban mis padres me lancé a imitar lo que había visto: cogí una patata, la pelé y corté, puse aceite en la sartén y las freí, observando de puntillas la mágica transformación. Pese a la posible imprudencia, esta experiencia creativa me causó un gran impacto y decidí repetirla numerosas veces. Por otra parte, mis abuelos tenían una casa en el campo y me enseñaron a trabajar la tierra y recoger sus frutos. Sinceramente, el campo no siempre me gustó. No me hacía mucha ilusión madrugar un domingo para ir a recoger olivas y helarme de frío. Pero, con el tiempo, la semilla de la naturaleza germinó, creció y se convirtió en una gran pasión: todas esas horas de trabajo y observación me hicieron apreciar todas las maravillas que encierra la naturaleza. Además, mi padre, profesor de física y química, siempre se preocupó por enseñarme formulas químicas y curiosidades científicas que despertaron en mí un gran interés por conocer e investigar los secretos escondidos en moléculas, seres vivos o sistemas planetarios. La mezcla de todos ingredientes precipitó que decidiera estudiar Ciencias Ambientales, quizás no era la carrera con más futuro, pero sí la que más me ilusionaba. Más tarde, me aventuré como alumno interno en el Departamento de Ecología de la Universidad de Murcia para conocer de primera mano el mundo de la investigación. La experiencia me encantó y al acabar la carrera quise empezar una tesis doctoral. Todavía recuerdo con gran emoción el día que conseguí el contrato para hacer la tesis. Fue una alegría enorme y el principio de una gran aventura. Por aquel entonces, ni me podía imaginar las grandes experiencias que vendrían, los retos, las personas que conocería o los momentos difíciles y gloriosos en los que me vería envuelto. Sin duda, la tesis es un gran viaje en el que se sabe dónde se empieza pero nunca dónde vas a acabar. Os quiero contar aquí los aprendizajes principales que me ha enseñado la ecología durante la tesis y en etapas posteriores.
La diversidad de la vida y su respuesta al cambio global
Una de las características de la vida es su potencial evolutivo y adaptativo, que ha hecho los seres vivos conquisten hasta el último rincón del planeta. De entre los millones de especies que habitan la Tierra -lo que llamamos biodiversidad- muchos viven en zonas muy productivas y benignas, como los bosques tropicales, mientras que otros han sido capaces de colonizar las zonas más inhóspitas del planeta como los desiertos o tundras.

Fig. 1. (a) Muestreando un río en Murcia, (b) Río Lozoya (Madrid), (c) Campaña de muestreo en Marruecos. Dos ejemplos de insectos acuáticos (c) adulto volador de caballito del diablo y (d) escarabajo acuático, Fotos a, b, c y e: Ecología Acuática, UMU. Foto d: www.flagstaffotos.com.au(Licencia CC 3.0)
Todos ellos tienen adaptaciones biológicas que les permiten sobrevivir, colaborar y competir dentro de un rango de condiciones en el cual pueden desarrollar su ciclo vital. Por ejemplo, algunas plantas, como los cactus, son capaces de hacer la fotosíntesis sin apenas perder agua, mientras que otros organismos poseen enzimas que les permiten resistir temperaturas extremas. Sin embargo, las actividades humanas como la destrucción de hábitats naturales, la agricultura o el cambio climático, están cambiando las condiciones del planeta y llevando a muchos organismos al borde de la extinción. Este proceso se conoce como cambio global y supone un gran problema.
Para comprender mejor cómo se pierde la biodiversidad en respuesta a este cambio global, hemos estudiado qué características hacen que los organismos sean más o menos sensibles a las presiones humanas usando los ríos como ecosistema modelo (Fig. 1).En general, vemos que la pérdida de hábitats naturales reduce la biodiversidad en todas sus formas: número de especies, diversidad de adaptaciones biológicas y diversidad de genes. Por ejemplo, hemos observado que los animales grandes o los depredadores suelen ser más sensibles a los cambios ambientales, en comparación con organismos pequeños y de mayor flexibilidad alimenticia.
La importancia de la biodiversidad
Al igual que en el deporte o en la música cada miembro de un equipo o de un grupo juega un papel distinto y fundamental, que contribuye al resultado final, ya sea ayudando a ganar un partido o haciendo que una canción suene bien.
Si hablamos de un equipo de fútbol (Fig. 2a), veremos que hay cuatro funciones fundamentales: portero, defensa, centrocampista y delantero. Curiosamente, veremos que los 11 jugadores no se distribuyen de manera equitativa entre las cuatro funciones, ya que la mayoría de jugadores son defensas y los centrocampistas, que suman normalmente ocho. Para los que no os guste el fútbol, podéis pensar en una orquesta donde podremos encontrar varios instrumentos, donde algunos, como los violines, son mucho más frecuentes que el piano o la percusión. Si hiciéramos un experimento y fuéramos eliminando jugadores o músicos al azar, al tiempo que evaluamos cómo cambia el juego del equipo o la melodía, podríamos averiguar la importancia de cada elemento, jugador o músico, en estos sistemas. Así, imaginad que quitamos a un elemento que no está repetido, por ejemplo, el portero o la percusión. En este caso, es posible que el sistema no sea capaz de desarrollar un funcionamiento correcto, por ejemplo, encajando muchos goles o perdiendo el ritmo.

Fig. 2. (a) Equipo de fútbol, (b) ecosistema natural. Fotos: Boletusedulis (Autor: Strobilomyces), musgo (B. Blaylock), esparto (C. Niehaus), pino carrasco (Accurimbono), líquen (J. Hollinger), abeja (Jon Sullivan), mariquita (libre), conejo (J.J. Harrison), salmón (T. Knepp), lobo ibérico (A. de Frías Marqués) y oso pardo (F.C. Franklin).(Licencia CC 3.0)
Uno de los hallazgos más apasionantes en los últimos 20 años de ecología ha sido comprobar que la naturaleza juega como un equipo o un grupo de música a la hora de proporcionar funciones ecosistémicas (Fig. 2b), como la producción primaria o el reciclaje de nutrientes. Anteriormente, los ecólogos pensaban que el clima, el suelo u otras condiciones ambientales eran los motores principales de estas funciones. Sin embargo, recientemente hemos observado que la diversidad de organismos incrementa notablemente el número de funciones ecológicas que proporciona un ecosistema. Estas funciones son clave para la producción de alimento, madera o fibras naturales y para la capacidad reparadora de los ecosistemas. Por lo tanto, preservar la biodiversidad es esencial para garantizar que podamos seguir teniendo tierras fértiles, agua potable o mares productivos. En resumen, la biodiversidad es clave para nuestra supervivencia.
La naturaleza como maestra
Si hay algo que he aprendido es que no hay mejor maestra que la naturaleza. En nuestra corta estancia en este planeta (aproximadamente, unos 200.000 años), los humanos hemos avanzado mucho, pero estamos muy lejos de los logros de la naturaleza. La vida apareció en la Tierra hace unos 3.800 millones de años y, desde entonces, ha superado todos los retos imaginables, descubriendo los secretos de la sostenibilidad y la armonía. En estos momentos nos enfrentamos a la mayor crisis ambiental que hemos sufrido en toda nuestra historia, donde que la acción conjunta del cambio climático, el agotamiento de recursos y el aumento de la población mundial están causando problemas sin precedentes. Nuestro modelo económico y social es el motor de estos problemas y urge encontrar una alternativa. En este sentido, la naturaleza nos ofrece un modelo que ha persistido a lo largo del tiempo, que se basa en los recursos locales, energías renovables y diversidad. Nuevas disciplinas, como la biomímesis, están combinando la ecología con la agricultura, la arquitectura o la ingeniería para diseñar agricultura diversa y de bajo impacto o construyendo trenes más eficientes inspirados en el martín pescador. Aprendamos de la naturaleza a hacer un mundo mejor. Aprovechemos que hay muchos investigadores con ganas de explorar más allá del horizonte y compartir su botín con la sociedad.
Cayetano Gutiérrez Cánovas
Doctor en Biología; Investigador postdoctoral – Juan de la Cierva, Universitat de Barcelona
Dicen que los niños no mienten. Hay niños a los que les encantan las máquinas. Otros que se pasarían todo el día subidos a una bicicleta. O pegados a una pantalla. O aporreando una batería. Y hay otros que disfrutan curioseando por el campo o en el jardín de su casa, observando bichos o persiguiendo lagartijas. Sea cual sea la actividad que los mantenga ensimismados, es más que probable que aquello que llamamos vocación guarde relación con esa actividad. Y aquello en lo que muestren más interés, será sin duda donde más realizados se sientan si, a lo largo de su vida, consiguen dedicarse profesionalmente a ello. Y tanto más cuanto más logren difuminar esa línea que separa afición de trabajo.
Hay algo intrínsecamente ligado a nuestro ser que nos empuja a observar e intentar comprender el mundo natural que nos rodea. Nuestro entorno. Es por ello que la Ecología es posiblemente la ciencia más antigua que existe. Nuestros primitivos ancestros debieron atesorar un conocimiento exhaustivo de las potenciales utilidades de toda una variedad de seres vivos con los que cohabitaron, desde hongos a plantas y animales. De su capacidad para observar, aprender y utilizar los recursos naturales dependía su supervivencia. Debían conocer qué alimentos aparecían en qué lugares y en qué momento del año. Dónde encontrar agua. Intentar predecir el clima. Y resguardarse de sus inclemencias. Evitar ser comidos. Eludir y paliar las enfermedades. Hubieron de aprender a optimizar su interacción con las demás especies de su entorno, y con sus congéneres. Exactamente tal y como sucede hoy en día, aunque el desarrollo tecnológico que parece haber alcanzado nuestra especie contribuya a que con frecuencia se nos olvide que no somos sino un ser vivo más, un simple eslabón del ecosistema, y que nuestro bienestar y supervivencia dependen, mucho más íntimamente de lo que creemos, de los demás seres vivos de nuestro entorno. Cada día.
La palabra Ecología proviene del griego Oikos, que significa casa, hogar. Se dedica por lo tanto al estudio de nuestro entorno, sea éste inmediato o lejano según dónde consideremos que están los límites de nuestro hogar. Una definición más precisa de la Ecología sería el estudio científico de las interacciones entre los seres vivos y con su medio ambiente. El medio ambiente engloba todos aquellos factores que influyen sobre un organismo, e incluye factores abióticos como la temperatura o la precipitación, y factores bióticos como son otros organismos de su misma y de otras especies. Tras unos inicios más orientados al estudio de los primeros, una de las vertientes más apasionantes de la Ecología moderna se centra en los segundos factores, en determinar cómo se modulan las interacciones entre organismos. Si bien existen otras, las tres principales interacciones que se producen entre los seres vivos, y que gobiernan en gran medida su distribución y abundancia, son la competencia, la depredación y el parasitismo. Al igual que antes, las dos primeras fueron abordadas tempranamente por la Ecología. Por el contrario, el estudio del parasitismo es más reciente, y se vio favorecido por el desarrollo de técnicas apropiadas para poder observar a los parásitos, que son con frecuencia seres de pequeño tamaño.
En Ecología se trabaja siempre al amparo de un marco evolutivo, pues nada en biología tiene sentido si no es a la luz de la evolución. Ninguna otra idea en biología es tan poderosa científicamente ni tan estimulante intelectualmente como la evolución. La teoría de la evolución propuesta por Charles Darwin en "El origen de las especies" es seguramente la idea más importante e influyente desarrollada por la mente humana. Nos proporciona el prisma necesario desde el que observar y comprender nuestro alrededor, y nos permite ir respondiendo a preguntas fundamentales que abarcan desde el origen mismo de la vida y de nuestra existencia, pasando por la gestión y manejo de nuestro entorno, hasta elaborar predicciones sobre lo que nos deparará el futuro a medio y largo plazo. La evolución biológica puede definirse como el cambio en las características de las poblaciones de organismos a lo largo de las generaciones. Este cambio se produce gracias a la otra idea brillantemente vislumbrada por Darwin: la selección natural. Ésta tiene lugar siempre y cuando exista variabilidad en alguna característica, que determine diferencias en fecundidad y/o supervivencia entre individuos, y que sea heredable. Y estas tres características ocurren en todas las poblaciones de seres vivos. Incluidos nosotros mismos, por supuesto.
Así, como no podría ser de otra manera, la Ecología, al igual que su objeto de estudio, es una ciencia en constante evolución. Si en el siglo pasado estuvo enfocada principalmente a la descripción de nuestro medio ambiente, en la actualidad nuestra sociedad nos enfrenta a nuevos retos. La población humana del planeta continúa incrementándose de modo aparentemente inexorable. Esta superpoblación conlleva unas consecuencias de las que todos somos en mayor o menor medida conscientes, originadas principalmente por la necesidad de obtener alimentos y recursos para una población cada vez más numerosa. La destrucción o modificación de la naturaleza para proveer campos de cultivo o pastos para la producción de ganado, el agotamiento de los recursos pesqueros, el cambio ambiental global, la extinción de especies, o la contaminación y acumulación de residuos, son solo algunos ejemplos de lo que la expansión de nuestra especie por el globo ha provocado, y cuyos efectos se han acentuado tras las revoluciones industrial y tecnológica. Algunos investigadores incluso consideran que nos enfrentamos a una nueva era planetaria que han dado en llamar el antropoceno. Hoy más que nunca, la sociedad llama a la puerta de la investigación para demandar soluciones. Y los Ecólogos estamos en disposición, como ningún otro sector de la sociedad, para sentar las bases que proporcionen herramientas y respuestas a los desafíos a los que nos enfrentamos y que amenazan nuestra supervivencia en el planeta. Tan sólo integrando la información recabada por Ecólogos y Biólogos Evolutivos en sus amplios y variados campos de investigación, podremos garantizar el equilibro de los diferentes ecosistemas que habitamos.
En la práctica, el trabajo de un Ecólogo comienza observando la naturaleza y planteándose preguntas a las que poder dar respuesta. Esas preguntas son infinitas y pueden ser de muy diversa índole: ¿Para qué le sirve la cola al pavo real? ¿Por qué existen leones sin melena? ¿Cómo saben las golondrinas cuándo emprender el vuelo hacia África? ¿Por qué los mosquitos pican más a unas personas que a otras? ¿Cómo afecta la deforestación del Amazonas al clima mundial? ¿Por qué las flores son de los colores que son? ¿Por qué saltan los delfines? ¿Por qué nos atraen las personas con los ojos verdes? … Una vez definida la pregunta a la que deseamos dar respuesta, un Ecólogo plantea hipótesis sobre esa función, ese mecanismo, ese comportamiento, o ese proceso, y formula predicciones sobre lo que ha de ocurrir en caso de que esas hipótesis sean ciertas. A continuación, diseña investigaciones concretas decidiendo qué datos y mediciones necesita tomar, o qué muestras es necesario recolectar para poder responder a esas preguntas. Posteriormente procede a analizar esas muestras, y luego, mediante análisis estadísticos, interpreta esos datos para comprobar la validez de sus hipótesis. El trabajo de un Ecólogo finaliza dando a conocer los resultados de sus investigaciones, usualmente en forma de artículos científicos y comunicaciones en congresos. De este modo, el conocimiento se va acumulando, puede ser utilizado por otros investigadores, percola en la sociedad, y lleva al planteamiento de nuevas preguntas, para así conocer cada vez mejor el mundo que nos rodea. Nuestro hogar.
Para dar respuestas a esas preguntas, un Ecólogo ha de aventurarse a menudo en lugares naturales fascinantes (Fig. 1). Personalmente, he tenido la fortuna de poder realizar trabajo de campo para mis investigaciones, o para asistir a colegas en sus estudios, en frondosos bosques de varios Parques Nacionales de España y de los Países Bajos, en las laderas de un volcán de México, en las islas Galápagos, en la selvas de la Amazonía, en bosques tropicales secos de Ecuador, o en una isla paradisíaca (¡con una única palmera!) perdida en el océano Pacífico. Muchos de estos lugares son con frecuencia inaccesibles para el público general.

Fig. 1. El autor del artículo con un tucán capturado en las selvas de Ecuador, dentro de una investigación acerca del efecto de la destrucción del bosque tropical sobre la comunidad de aves y sus parásitos (foto: Juan Rivero).
Esos períodos de trabajo de campo suelen ser alternados con etapas de análisis de muestras en el laboratorio, y con períodos de oficina frente a un ordenador. Por tanto, el del Ecólogo es un oficio diverso y que requiere una combinación de ejercicio físico, usualmente con un toque de aventura, mezclado con destrezas y habilidades manuales, y con desafíos intelectuales… ¡es difícil aburrirse!
La naturaleza es maravillosa. Y dedicarte cada día a desentrañar los procesos y mecanismos que han creado, y continúan haciéndolo, esa diversidad, esa belleza que observamos, es genuinamente gratificante. Nos adentramos siempre en el mundo de lo desconocido. Seguimos jugando. Como cuando éramos niños. Brindo porque nunca dejemos de serlo.
Gustavo Tomás Gutiérrez
Doctor en Biología; Estación Experimental de Zonas Áridas (EEZA-CSIC), Almería
Desde muy pequeño la ecología fue parte de mí, aunque yo no supe lo que era hasta una avanzada edad. ¿Ecología?, que palabra más rara pensaba, dícese de la ciencia que estudia las funciones e interacciones de los organismos con su entorno, el ecosistema. Pero, ¡si es esto mismo lo que llevo haciendo desde muy pequeño! Crecí, hijo de una familia humilde de agricultores, pasándome los días enteros correteando por los campos, cultivos de mi familia y sus alrededores, aunque algún que otro día, también me tocaba echar una mano en las tareas agrarias y en casa, había que arrimar el hombro. Mi vida transcurría entre el colegio y el campo, donde buscaba y observaba todo aquel bichito o animal que se moviera por el suelo o debajo de las piedras.
Mis primeros estudios, ya con 10 años trataron sobre la cría en cautividad de los caracoles (Theba pisana en este caso) con alimentación a base de lechuga Iceberg en cajas de zapatos, lástima que en mi época todavía no había ordenadores ni internet disponibles para poder registrar esta información, en fin!. A medida que iba creciendo conocí mejor la fauna de mi entorno. Contaba y estudiaba los nidos de avión común de mi instituto (Delichon urbicum, una avecilla muy bonita parecida a una golondrina que construye nidos con barro en las paredes y techos, como si fuera un maestro alfarero). También localizaba en el huerto de limoneros de mi tío Manolo, los nidos de las gafarrillas (nombre vernáculo que se le da al verdecillo (Serinus serinus), un pequeño pajarillo de gran parecido al canario, que cría en los árboles). Posteriormente anotaba y dibujaba en un cuaderno en qué árbol y parte del huerto estaban localizados cada uno de ellos. Iban pasando los días y crecía observando nidos de distintas especies de aves que habitaban en mi entorno, unos hechos de barro y situados en las paredes, otros con ramitas y hojas en los árboles, incluso llegué a encontrar nidos de una pequeña ave rapaz nocturna, el mochuelo (Athene noctua, mi ave favorita y que representa a la diosa griega Athenea). Siempre recordaré mientras viva, aquel maravilloso instante, en que encontré por primera vez un nido de este depredador alado. Allí me encontraba yo, acompañado de uno de mis mejores amigos, Tomas García, en una mañana de marzo, junto a un garrofero solitario (Ceratonia silicua). Aquella mañana soleada, dio un vuelco a mi vida, tras mirar aquel atractivo agujero de ese hueco árbol, una gran sorpresa y consecuente alegría inundó nuestros tiernos cuerpos. El descubrimiento del que sería el primer nido de mochuelo que observáramos en nuestras vidas, que con cinco esféricos huevos de un blanco nacarado perfecto, nos hizo dar hasta volteretas y piruetas aéreas. Este acontecimiento marcó el comienzo de una gran andanza y trayectoria en mi vida tomando aún un mayor interés sobre la ecología de las especies de nuestro alrededor.
A partir del hallazgo de mi primer nido de mochuelo, comencé el seguimiento de este nido con atención durante años (observando y contando el número de pollos que sacaban adelante cada año), y a disgusto también presencie la posterior desaparición de aquel viejo algarrobo. Al parecer, este magnífico árbol estorbaba a los grandes tractores y maquinarias agrícolas de nueva generación para trabajar la tierra. Este hecho, me enojó bastante y dio un poco más de sentido a mis observaciones de campo. Pues cada año que pasaba se perdían lugares de nidificación de muchas especies, y era más difícil verlos o localizarlos. En mis cuadernos de campo anotaba cómo las poblaciones de muchas especies de aves eran cada vez más escasas, pero no conocía el porqué.
¿Sabéis qué? Una pareja de Athene noctua puede consumir varios millones de presas al año, con una dieta compuesta principalmente por insectos, lombrices, pájaros, roedores de pequeño tamaño y musarañas, y que esta voracidad alimenticia, resulta de gran beneficio a la agricultura, ya que estas aves nos ayudan, consumiendo las especies de insectos más abundantes que encuentran, a que no se produzcan plagas que dañen los cultivos, por lo que, como resultado, son capaces de regular el tamaño de esas poblaciones.
Muchas fueron las series documentales sobre fauna y flora salvaje vistas desde mi infancia, en las que observaba la vida de los osos, las grandes águilas y búhos que habitaban nuestras sierras. Muchos de estos documentales fueron realizados por Félix Rodríguez de la Fuente, gran comunicador y amante de la Naturaleza, que realizó una gran labor de concienciación y divulgación de la fauna y flora de la Península Ibérica y del Planeta. Gracias a estos reportajes también descubrí una gran diversidad biológica de ambientes y distintos tipos de vida. Mi mente inquieta, se preguntaba ¿donde están esos osos, águilas y búhos que veía en la pantalla?, ¿dónde viven?, ¿por qué no hay aquí donde yo vivo?, ¿estarán en las montañas que veo a lo lejos?

Poco después ya en la adolescencia, conocí a mi gran maestro Eloy Pérez Romero, 20 años mayor, un naturalista intrépido hecho de una casta poco habitual, que recorría con sus fuertes piernas cualquier rincón agreste o paredes rocosas de las sierras que nos rodeaban. Él fue quien me mostró dónde estaban esas grandes águilas y búhos, fue quien me transmitió el secreto. Efectivamente, estas aves vivían en las montañas que yo veía de lejos desde los campos de mi familia. Mi adolescencia estuvo llena de descubrimientos, Eloy me enseño a observar y buscar dónde anidaban las aves rapaces en las abruptas montañas acantiladas que nos rodeaban. Por un lado, las grandes águilas que viven durante el día, construían grandes plataformas con ramas de árboles y matorrales, que situaban en las paredes rocosas más altas que pudiéramos observar. Por otro lado, el gran duque o el búho real (Bubo bubo), ave rapaz nocturna y señor de la noche, escarbaba sus nidos en el suelo terroso de oquedades o agujeros situados en pequeños roquedos escondidos en las cárcavas y barrancos de estas sierras.
Cuando terminé el instituto, llegó la Universidad. Comencé a estudiar la antigua Licenciatura de Biología, y conocí la "Ecología". Mis profesores, catedráticos y alumnos de Doctorado, inundaban mi mente con todas las herramientas necesarias para estudiar y comprender cómo evolucionaban las poblaciones de los animales que me gustaban, y qué hacer para que esas poblaciones no desaparecieran por culpa de las incontroladas acciones del ser humano. Ya no sólo era la modernización de la agricultura, sino la construcción de grandes vías de comunicación, como las autovías y trenes de alta velocidad, los grandes proyectos urbanísticos o urbanizaciones masivas, así como las líneas eléctricas, que también son un peligro para la fauna. Ya no era sólo la acción directa de una escopeta o un veneno, sino la desaparición de los hábitats y lugares donde viven estas especies en la naturaleza, lo que amenazaba su supervivencia. Así, la biología de la conservación hizo su aparición, y dio más sentido a mi trabajo.
¿Qué es la biología de la conservación?
La biología de la conservación es la disciplina científica asociada a la ecología, que se ocupa de estudiar las causas que provocan la pérdida de diversidad biológica o biodiversidad, y de cómo minimizar esta pérdida. Efectivamente esta era la disciplina que debía usar para estudiar y comprender las causas que producían la pérdida de biodiversidad biológica que a mi tanto me preocupaba y poder tomar medidas y soluciones para conservar las especies y los ecosistemas que nos rodean, tan necesarios para la vida de los seres humanos y que por desconocimiento o despreocupación estamos destruyendo.
Así que decidí embarcarme en una Tesis Doctoral en esta disciplina científica. Ya por aquel entonces, y sin saberlo, junto a Eloy y José Alfonso Lacalle, otro gran amigo, fotógrafo y naturalista, controlábamos la población de búho real que se conozca más grande del mundo, anotando las observaciones y visitando más de 150 territorios de cría de estas magníficas aves. De esta manera, y aprovechando el control que ya realizábamos sobre una población de esta especie, tan desconocida, decidí embarcarme en la realización de nuevas investigaciones y estudios científicos, para desvelar qué función realizaba este ave en los ecosistemas y cómo era su interacción con el ser humano.

Mi tesis: "Estudios ecológicos de poblaciones de búho real en la Península Ibérica: ocupación territorial, reproducción, supervivencia y estructura genética", quería dar a luz a través de estas raras palabrejas, ciertos aspectos antes desconocidos de esta especie y que podían ser de gran ayuda para la conservación de esta y otras especies de aves rapaces. Por ejemplo, en el estudio de la supervivencia de esta especie, descubrimos que los búhos reales morían electrocutados con mucha frecuencia al posarse en los postes y cables de las líneas eléctricas que abastecían de energía y luz eléctrica nuestros hogares. De esta manera pudimos reaccionar y cambiar los cables, aislándolos y tapándolos con fuertes plásticos que no dejan pasar la corriente, consiguiendo que estas aves ya no se electrocutaran cuando se posaban. ¿Y sabéis, qué es lo que lleva a estas aves a morir electrocutadas? Resulta que una de sus estrategias de caza está basada en realizar acechos posados en atalayas o lugares altos, para dar caza a sus presas. En este caso resulta que los postes eléctricos hacen de posaderos simulando arboles, donde estas aves al posarse pueden correr el riego de electrocutarse.
Como veis la biología de la conservación, a través de observaciones en campo, el control de poblaciones de especies o incluso con experimentos en el laboratorio, ya sea estudiando aves rapaces, plantas, insectos o microorganismos, trata de estudiar y resolver problemas sobre las interacciones de estas especies, su hábitat y el ser humano. En la actualidad, el gran y veloz desarrollo humano está haciendo que no tengamos mucho en cuenta la tierra, la naturaleza y los ecosistemas en los que vivimos, siendo necesario el estudio y observación de las especies y de los procesos naturales asociados con el ser humano, para no perjudicar el lugar y planeta Tierra que habitamos, es aún pronto para poder vivir en un sitio tan desolado, sin vegetación y sin animales como la Luna o Marte.
Mario León Ortega
Doctor en Ecología
Investigador Licenciado, Universidad de Murcia
Hasta hace no muchos años se pensaba que el mar, como es tan grande, podía servir para echar allí toda la basura que los seres humanos generan. Las industrias comenzaron a funcionar en países donde aún no lo habían hecho, y los países que ya tenían sólidas industrias aceleraron su producción para no quedarse atrás… en definitiva, la cantidad de residuos, en ocasiones tóxicos, que los humanos producimos se ha ido incrementando mucho en los últimos cincuenta años. Y nadie se preocupaba de a dónde iba todo ese material de desecho. Y sí: de una manera o de otra, casi toda esa basura acaba en el mar.

Fig. 1. Muestreo de sedimento para ensayos de toxicidad. (Fotografía de Fernando Rey).
Sin embargo, a partir del último cuarto del siglo XX, los científicos comenzaron a dar la voz de alarma acerca de las consecuencias de la falta de control sobre los residuos humanos. De la antigua teoría de la dilución (en el mar cabe toda la basura que echemos: todo se irá diluyendo) se pasó a una nueva, que se denominó la teoría del boomerang: todo lo que echemos al mar, tarde o temprano… va a volver [1].
Pero, ¿cómo conocer el efecto que esas basuras (sólidas, líquidas o gaseosas) tienen sobre los ecosistemas? Para comprobarlo hacen falta científicos especializados en el tema: los ecotoxicólogos.
¿Qué es la ecotoxicología?
La ecotoxicología es una disciplina científica que estudia los efectos que sobre los seres vivos causan las sustancias que los humanos liberamos al medio ambiente. Esas sustancias, de forma natural, no existirían en la naturaleza (por eso se denominan "sustancias xenobióticas", es decir, de origen ajeno a la vida). Estos estudios se pueden llevar a cabo a nivel molecular (enzimas, ADN, composición química), a nivel de tejidos, o de individuos, o de poblaciones, o incluso de ecosistemas enteros. Es un campo muy complejo que requiere conocimientos en química, en biología, en fisiología, en taxonomía, en ecología… incluso en geología y climatología. El objetivo de los ecotoxicólogos es alertar acerca la peligrosidad de determinadas sustancias para el medio ambiente. Una vez que estos científicos han determinado que ciertas sustancias son peligrosas, entonces (y ¡ay!, solo entonces), los poderes de los estados pasan a tramitar leyes que controlen la producción, el consumo y los vertidos de tales productos, y los tribunales a encausar a quienes se salten esas leyes. Los ecotoxicólogos, pues, ejercen una labor de vigilancia sobre el estado de salud de los ecosistemas.
¿Un ejemplo?
Cuando yo era pequeño, en la enciclopedia que había en mi casa, uno buscaba la entrada para el DDT, y el texto, escrito en los años sesenta del pasado siglo, decía que esa sustancia (un insecticida que en realidad se llama diclorodifeniltricloroetano), era una maravilla, y que no tenía efecto sobre otros organismos que no fueran los insectos.

Fig. 2. Un científico (el Dr. Luis Lubián) analizando la variación de las poblaciones de microalgas marinas a bordo de un buque oceanográfico. (Fotografía de Cristina González).
Con él se podían controlar plagas de mosquitos que transmitían distintas enfermedades, sin causar daño al medio ambiente. Pero en realidad esa afirmación no tenía ninguna base científica. Los ecotoxicólogos empezaron a hacer pruebas y resultó que una vez que el DDT entraba en un organismo, se biomagnificaba al formar parte de las redes tróficas. Es decir, que las algas y las plantas tenían cierta concentración de DDT que habían absorbido del medio ambiente, los herbívoros que se las comían tenían concentraciones mucho más altas que las plantas y algas, los carnívoros aún cientos de veces más que los herbívoros, y los denominados superpredadores (que son depredadores incluso de otros depredadores), tenían tales niveles de DDT en sus cuerpos que podían comprometer seriamente su salud o su reproducción. Esto incluía a tiburones, atunes, pájaros marinos, osos polares… y humanos. A pesar de que en Estados Unidos se prohibió su fabricación y uso en 1972 (prohibición que se extendió progresivamente a todos los países del mundo), aún hoy es posible encontrar DDT en la leche materna de los humanos [2].

Fig. 3. Participante en una campaña oceanográfica a bordo del buque Oceanográfico de la Armada Hespérides. (Fotografía de la Expedición Malaspina).
El problema, que se puede alargar durante siglos, radicó en la falta de ensayos ecotoxicológicos antes de que el DDT se produjera industrialmente.
¿Por qué hay que vigilar el mar?
Como ya se ha comentado, gran parte de la basura y las sustancias contaminantes que los humanos generamos tienen por destino el mar. Es necesario un estudio profundo para saber, por ejemplo, cuánto duran los plásticos en el mar y cómo afecta a la fauna: hoy sabemos que las tortugas confunden plásticos con medusas de las que se alimentan, y como no son capaces de digerirlos, podrían morir cuando los comen.
Pero ver eso es fácil, las tortugas son grandes. Sin embargo, ¿cómo afectan plásticos más pequeños a otros animales de menor tamaño? ¿Y los trocitos de plástico microscópico, a quién podrían afectar [3]?
¿Qué pasa con los componentes de las cremas solares que los bañistas se ponen sobre la piel? ¿Son inofensivos para todos los organismos marinos [4]…?
Y como estas preguntas, otras muchas. El ritmo de producción de sustancias nuevas para distintos usos es muy alto, y no siempre se realizan ensayos para determinar su peligrosidad. Estas sustancias nuevas aún no testadas podrían ser peligrosas, y se denominan contaminantes emergentes [5]: productos de cuidado personal, fármacos, nanopartículas… Hay mucha labor por hacer, aún, en el campo de la ecotoxicología marina.
A modo de conclusión
Los ecotoxicólogos marinos tienen la labor, pues, de determinar la presencia o no de los distintos tipos de contaminantes en el medio ambiente y de determinar el efecto que estos productos de origen humano tienen sobre la fauna y la flora marina, con objeto de preservar un planeta limpio y saludable para las generaciones futuras. Agotar los recursos y ensuciar el planeta es una actitud propia de seres egoístas que no tienen en cuenta las necesidades que tendrán sus hijos y sus nietos. Y cuidar del planeta (y de sus océanos) es una simple cuestión de voluntad. Solo hay que querer hacerlo.
Referencias:
[1] Newman, M.C. &Unger, M.A., Ed. 2003. Fundamentals of ecotoxicology, 2ndedition. CRC Press, Boca Ratón. Lewis Publishers.
[2] Man, Y.B.; Chan, J.K.Y.; Wang, H.S.; Wu, S.C. and Wong, M.H. 2014. DDTs in mother’s milk, placenta and hair, and health risk assessment for infants at two coastal and inland cities inChina. Environment International 65:73-82.
[3] Isobe, A.; Uchiyama-Matsumoto, K.; Uchida, K. and Tokai, T. 2017. Microplastics in theSouthernOcean. Marine PollutionBulletin 114: 623-626.
[4] Sendra, M.; Sánchez-Quiles, D.; Blasco, J.; Moreno-Garrido. I.; Lubián, L.M.; Pérez-García, S. & Tovar-Sánchez, A. 2016. Effect of TiO2 nanoparticles and sunscreens on coastal marine microalgae: Ultraviolet radiation is key variable for toxicity assessment. Environment International 98: 62-68.
[5] Naidu, R.; Arias España, V.A.; Liu, Y. and Jit, J. 2016. Emerging contaminants in the environment: Risk-based analysis for better management. Chemsophere 154: 350-357.
Ignacio Moreno Garrido
Licenciado en Biología, especialidad Botánica; Doctor en Ciencias del Mar; Científico Titular del Instituto de Ciencias Marinas de Andalucía (CSIC). Director del Departamento de Ecología y Gestión Costera.
El vino en la historia y el bagaje cultural de la humanidad
Mucho antes de que los factores microbiológicos y bioquímicos involucrados en la fermentación alcohólica fueran dilucidados por Pasteur en 1857, los hombres ya podían producir vino. Tanto los biólogos como los historiadores localizan el nacimiento de la vitivinicultura en las montañas del Cáucaso en Transcaucasia y en Anatolia. Hacia el VI milenio a.d.C. ya existía una verdadera cultura del vino. Los restos más antiguos de uvas domesticadas (Vitis vinifera), se encontraron en el poblado neolítico de Shulaveris-Gora, situado en el actual país de Georgia. En los años 20 del siglo pasado arqueólogos rusos y armenios descubrieron en el palacio de los reyes urarteos en la ciudad de Teishebani (hoy día parte de la capital armenia Erebán) un enorme almacén equivalente a 35 hectáreas con más de 150 salas; varias servían de bodegas. A lo largo de los siglos, una vez abandonado el lugar, las tinajas perdieron su contenido, conservando únicamente, eso sí, una capa muy fina de residuos, éstos contenían ácido tartárico, un ácido característico de la uva que confiere al vino su valor característico de pH (3,00-3,50) y su peculiar acidez. Aunque no es posible deducir de qué tipo de uva se trataba, la presencia de este ácido en relativa abundancia indica que todos estos recipientes originalmente contenían vino. La Biblia es una fuente fundamental del simbolismo de la vid y el vino, y de hecho el cristianismo adoptó el "vino teológico" para simbolizar la sangre de Cristo en la Eucaristía. Fenicios y griegos mostraron gran interés por esta bebida y su comercialización, si bien fueron los romanos los primeros que introdujeron el vino en las comidas. Pero la necesidad de consumir vino en la Edad Media se debía fundamentalmente a razones de salubridad, como substituto del agua, considerándose uno de los elementos fundamentales de la alimentación cotidiana. Actualmente el vino constituye uno de los sectores productivos más importantes de España y de otros países de Europa y se considera un producto distinguido en los países del nuevo mundo vitivinícola, como Argentina, Chile, Sudáfrica, Australia y Nueva Zelanda, y más recientemente China, que con unas 780.000 hectáreas de viñedo se ha convertido en el segundo productor de uva de vinificación, por delante de Italia y Francia, y amenazando a España como líder mundial. A día de hoy, el vino es venerado en torno a la gastronomía, considerándose el mejor acompañante de los platos y el producto que aporta mayor prestigio a una mesa [1].
El ADN de una copa de vino
El terruño o también conocido como ‘terroir’ es la suma de tres factores naturales: el suelo como factor estable, el clima como variable de cada añada y la variedad de uva. La combinación de estos tres factores ejerce un papel decisivo en la personalidad del vino. Los estudios de que disponemos han permitido secuenciar genomas de distintas variedades de uva y detectado multitud de genes ligados a propiedades físico-químicas, organolépticas o nutricionales. El suelo y más concretamente los microorganismos que componen el suelo del viñedo (se estima que 6 gramos de suelo pueden contener más de 1,9x105 especies distintas), está siendo en los últimos años el foco de nuevos estudios científicos como uno de los principales condicionantes de la composición de la uva y de la calidad y diferenciación de los vinos [2]. Además, existen proyectos en marcha encaminados a identificar de forma simultánea un elevado número de compuestos del vino que permitan trazar en su conjunto un espectro que podría asemejarse a la ‘huella dactilar’, lo que abre el campo a la búsqueda de marcadores de diferenciación, para múltiples aplicaciones, incluida la adaptación del sector vitivinícola al cambio climático.
En bodega, durante las etapas iniciales de la fermentación espontánea del mosto, predominan las especies de levadura comúnmente presentes en la superficie de la uva de los géneros Candida, Hanseniaspora y Kloeckera, seguidas por varias especies de Metschnikowia y Pichia(todas ellas colectivamente conocidas en el campo de la enología como levaduras no-Sacharomyces). Los niveles crecientes de etanol, la presencia de CO2 fermentativo y de agentes antimicrobianos, como los sulfitos, conducen a la sustitución casi invariable de estas especies por cepas de S. cerevisiae, mucho mejor adaptadas a las condiciones enológicas. Las levaduras no-Saccharomyces ofrecen actualmente una fuente inestimable de diversidad metabólica, que se puede combinar con las características bien conocidas de S. cerevisiae. La secuencia completa del genoma de S. cerevisiaefue publicada hace más de veinte años, lo que representó un hito en la era genómica como el primer genoma de un organismo eucariótico disponible públicamente, y abrió múltiples posibilidades para futuros estudios y aplicaciones industriales y potentes herramientas que han permitido grandes revelaciones y avances metodológicos de la biotecnología, tales como la genómica, proteómica o metabolómica. Después de la fermentación alcohólica, suele llevarse a cabo un segundo proceso llamado fermentación maloláctica (FML), especialmente en los vinos tintos. Este proceso está principalmente impulsado por Oenococcus oeni, una bacteria láctica bien adaptada a este entorno, aunque también puede tener un papel relevante la especie Lactobacillus plantarum. Durante la FML, el ácido málico se descarboxila a ácido láctico, lo que conduce a la desacidificación biológica del vino y a una mejora de su calidad organoléptica. Decenas de diferentes levaduras y bacterias lácticas se venden actualmente, muchas de ellas anunciadas como especialmente adecuadas para un determinado estilo de vinificación. La regulación estricta de los OGM (Organismos Genéticamente Modificados) y las demandas y preferencias de los consumidores, que plantean cuestiones relacionadas con la seguridad alimentaria y ambiental, han limitado su aplicación en la industria del vino. Este hecho ha estimulado una reactivación de métodos alternativos, no OGM. El éxito ya logrado sugiere que un número cada vez mayor de cepas de levaduras vínicas mejoradas llegarán al mercado en los próximos años, todas ellas habrán sido desarrolladas por técnicas no transgénicas.
Un inigualable estímulo a los sentidos a través de un buen vino
Hoy en día, el grado de aceptación de un producto alimentario está determinado en gran medida por sus propiedades sensoriales. Entre todas las bebidas, el vino es considerado probablemente como la más especial. Los grandes vinos no solo estimulan los sentidos del olfato, gusto y tacto, sino que se considera que pueden influir en las emociones y la conducta. Somos dependientes de nuestros sentidos para alcanzar el placer, pero no solo por el hecho de que nos informan de los colores que observamos, del aroma de un alimento o del roce de una mano sobre la piel sino por la capacidad que tienen para excitar la imaginación, para suscitar recuerdos y emocionarnos; en definitiva, para disparar los mecanismos cerebrales responsables de todo ello. El color es a través del sentido de la vista la primera sensación que se recibe de un vino y por tanto ejerce una clara influencia en la compra de una determinada marca, debido a un impuso visual decisorio. A continuación mediante la fase olfativa, apreciamos el aroma que junto con el color nos revela gran parte de las características de ese vino y marca en gran medida las preferencias por parte del consumidor. Percibiendo el aroma del vino podemos trasportarnos a recuerdos de nuestra infancia, a lugares que nos resultan inolvidables… En la vida cotidiana, los olores se perciben junto a múltiples señales visuales que se han integrado en la memoria. Sin embargo, es la fase gustativa la que tiene más peso en la valoración final. Este es el momento definitivo de la cata, y en la que más sensaciones se pueden percibir, ya que además del sentido del gusto propiamente dicho, también intervienen el del tacto y el del olfato. El sentido del tacto, a pesar de ser el menos estudiado, es el que parece tener mayor peso en la aceptabilidad y apetencia de un vino [3].
El color de un vino tinto depende en gran medida de su composición fenólica, y en particular, los compuestos responsables del color rojo son los antocianos, que se almacenan en las células del hollejo de las uvas tintas y durante la vinificación se favorece su extracción de la uva al vino. Los vinos jóvenes, debido a la presencia de antocianos libres presentan un tono rojo-azulado, mientras que el vino envejecido, por descomposición y reacciones de condensación de los antocianos con otros polifenoles (por ejemplo, taninos), presenta los tonos naranjas, que habitualmente se denominan en la cata, tonos "ladrillo o teja".
Las principales características de los compuestos que forman parte del aroma del vino son su elevada volatilidad y su bajo peso molecular (<500 Da), que les permite liberarse fácilmente en la matriz hidroalcohólica en la que se encuentran contenidos.

Fig. 1. Principales etapas que intervienen en la formación del aroma del vino.
Para que puedan ser percibidos como moléculas odorantes, deben además, contener un grupo osmóforo y estar presentes en una concentración superior a la de su umbral de percepción. Se puede considerar que el aroma del vino es el resultado de una serie de transformaciones químicas y bioquímicas que tienen lugar durante su producción (Fig. 1), que dan lugar a su gran complejidad y variación de un vino a otro. Tras el consumo del vino, la liberación del aroma va a estar condicionada por la acción de diferentes parámetros relacionados con la fisiología oral humana (anatomía de la cavidad bucal, temperatura, saliva, flujos respiratorios, mucosa oral), así como por los otros componentes de la matriz del vino y el mecanismo de reconocimiento del olor tras la unión de una o varias moléculas odorantes a sus correspondientes receptores olfativos, que genera un patrón de activación que el cerebro interpreta como un determinado estímulo (aroma a plátano, pimienta, regaliz, etc.), incluidas algunas desviaciones aromáticas como el "gusto a moho", debido a la presencia de 2,4,6-tricloroanisol (TCA) por contaminación en tapones de corcho y/o el ambiente de la bodega, y los desagradables olores a sudor de caballo y establo, producidos por la levadura alterante Brettanomyces durante la crianza en barrica, responsable del "carácter Brett" como se conoce en bodega. El desarrollo de la investigación y la innovación han permitido la aplicación de técnicas vitícolas y recursos enológicos para reducir su impacto e incluso erradicarlo.
El consumo moderado de vino y la salud desde la perspectiva de la ciencia
El vino, y en particular el vino tinto, es uno de los alimentos con más polifenoles, y además se caracteriza porque presenta una combinación única de estos componentes bioactivos. Todos sabemos que se trata de un producto alcohólico, por tanto, sus beneficios van siempre ligados al consumo moderado en personas sanas. Las primeras investigaciones sobre los efectos saludables del vino proceden de la década de 1990, entonces se publicaron resultados relevantes y empezaron a sucederse numerosos estudios epidemiológicos que llegaban a la misma conclusión de que el consumo moderado de vino podía tener efectos no solo sobre la prevalencia de enfermedades cardiovasculares, sino también sobre la de otras enfermedades crónicas o degenerativas. A medida que han evolucionado las investigaciones, hoy se dispone de resultados apoyados por laboratorios de todo el mundo, sobre sus propiedades beneficiosas avaladas en estudios en animales y, cada vez más, en estudios en humanos. El escenario que está emergiendo con más fuerza en los últimos años, es que los efectos de los polifenoles sobre la salud se explican por sus interacciones con la flora o microbiota intestinal [4]. La microbiota intestinal, y especialmente su funcionalidad metabólica es, en la actualidad, determinante en entender cómo evolucionará nuestra salud, por ello la estrategia se centra en conocer a fondo como los alimentos interaccionan con estas bacterias como principal perspectiva en el ámbito de la nutrición y la medicina. De hecho, en España varios grupos de investigación son punteros en la investigación para explicar cómo el vino y sus polifenoles ejercen un efecto beneficioso a nivel de la función y salud digestiva humana, y es de esperar que los avances que se produzcan en los próximos años, sitúen al vino entre los alimentos con un claro interés científico para nuestra salud y en la alimentación del futuro.
Referencias:
[1] M.V. Moreno-Arribas, ‘El vino’. CSIC-La Catarata (2011), ISBN: 978-84-00-09293-1, 99pp
[2] A.T. Palacios García, ‘Mitos y leyendas del vino’. AMV Ediciones (2017), ISBN: 978-84-945166-3-4, 244 pp
[3] F.J. Cudeiro Mazaira, ‘Paladear con el cerebro’, CSIC-La Catarata (2012), ISBN: 978-84-00-09502-4, 126 pp
[4] M.V. Moreno-Arribas, B.Bartolomé, ‘Wine safety, consumer preferences and health’ (2016), Springer Eds., ISBN: 978-3-319-24512-6 (version impresa) e ISBN 978-3-319-24514-0(eBook), 323 pp.
M.Victoria Moreno-Arribas
Doctora en Farmacia; Habilitada como Enóloga; Investigadora Científica del CSIC, Instituto de Investigación en Ciencias de la Alimentación (CIAL), CSIC-UAM
No voy a empezar diciendo que siempre quise ser gemóloga, ni que las gemas fueron mi pasión desde el día en que las descubrí ni que se despertó mi vocación a raíz de ningún fascinante episodio de alguna película. En realidad fue mi otro trabajo, el de verdad, el que me condujo a ellas y además, para ser sincera, tampoco me interesaron mucho al principio. Fue con el tiempo, a medida que las fui conociendo, cuando empezaron a cobrar verdadera importancia.
Antes de seguir adelante explicaré, para los que no estén familiarizados con el término, que la Gemología se ocupa del estudio de las gemas y que las gemas son todos aquellos materiales que por sus cualidades de belleza, durabilidad y rareza son susceptibles de ser empleados en joyería y ornamentación, como adornos personales o en objetos decorativos. La belleza es una cualidad muy ligada a propiedades ópticas como el color, la transparencia y el brillo. La durabilidad está ligada a otras propiedades como la dureza, un material bonito que se raye con facilidad perderá su belleza rápidamente y dejará de tener interés gemológico. Finalmente, la rareza está ligada a la escasez y la singularidad, son bienes únicos, propios de reyes y poderosos, inalcanzables para la mayoría de las personas.
Una vez dicho esto continuaré con mi historia, soy geóloga y mi trabajo de verdad es dar clase de Cristalografía en la Universidad. Al menos es lo que he hecho en los últimos cuarenta años. Como comprenderéis, en tanto tiempo "da tiempo" de hacer y pensar en muchas cosas además de dar clase. Con la Gemología me pasó eso, deseaba hacer algo muy diferente, algo original que no lo hiciera ninguna otra persona de mi entorno. Una afición que además de entretenerme pudiera serme de utilidad (quien sabe) en un futuro.
Y así fue. A pesar de la estrecha relación entre la Geología y el mundo de las gemas, ya que la mayoría de estas son variedades nobles de algunos minerales, ningún colega mío se decidió a hacer lo mismo a la vez que yo y después, a lo largo de mi trayectoria profesional, han sido muy pocos los que he ido encontrando. Una razón puede ser que el diploma de gemólogo es costoso ya que no hay centros oficiales en los que se pueda cursar. Son escuelas privadas las que ofrecen cursos, con un precio que suele ser directamente proporcional a su duración y sobre todo al número de prácticas y a la calidad de las mismas. Esas prácticas consisten en reconocer gemas, cuantas más mejor, así que, es fácil entender que se trata de un material caro y precioso.
Con esto quiero decir que son unos estudios con cierto carácter exclusivo lo cual, a la larga, puede resultar muy ventajoso. En mi caso supuso la creación de una asignatura de Gemología en la licenciatura de Geológicas de la Universidad Complutense –único centro en que estos estudios han tenido carácter oficial alguna vez– que tuve la suerte de impartir durante más de treinta años ya que era la única profesora que tenía esa titulación. Aprendí mucho sobre gemas durante ese tiempo y además resultó un contrapunto muy enriquecedor para mi otra actividad, la enseñanza de la Cristalografía.
La Cristalografía se debió iniciar como ciencia a raíz del interés que suscitaban los minerales, que son cristales naturales, con sus bellas formas y colores, en los antiguos científicos. Está claro que entre estos minerales las gemas debían ocupar un papel muy principal y el estudio de sus propiedades decisivo para el desarrollo de esta ciencia. El caso es que en la Gemología encontré no solo el objeto que fue clave para la ciencia de los cristales, sino que pude volcar en ella todos mis conocimientos cristalográficos, lo cual supuso para mí un precioso campo de experimentación real. Si en las clases de Cristalografía enseñaba los fundamentos teóricos de esta ciencia en las de Gemología realizaba las comprobaciones prácticas. Todas las cualidades de las gemas tienen una explicación científica que, además, puede tener interesantes aplicaciones prácticas y esto gustaba mucho a mis alumnos.
Conocer el origen del color, la transparencia o el brillo de una piedra preciosa. Saber que esas bellas formas de los minerales que tanto llamaron la atención de los primeros cristalógrafos están determinadas en parte por las peculiaridades de su estructura cristalina, es decir, por cómo se ordenan los átomos que la componen, "tal orden-tal forma". Y que también están influenciadas por las condiciones de crecimiento. Efectivamente, los cristales crecen y hay toda una teoría del crecimiento cristalino que se ocupa de ello y que tiene una importancia trascendental en la Gemología, que va más allá del mero entendimiento de la morfología cristalina.
Ya sabemos que una buena parte de las gemas son minerales. Estos pueden ser de origen natural, geológico como rubíes o esmeraldas, o biológico como perlas y corales. Sin embargo, también hay gemas cuyo origen no es natural que se llaman gemas artificiales y que se han cristalizado en un laboratorio, según las leyes y procedimientos dictados por esa teoría del crecimiento cristalino a la que me he referido anteriormente. Precisamente, el primer proceso de cristalización comercial viable que se describió fue la síntesis de una gema, el rubí, en el año 1902, por el químico francés Auguste Verneuil. A este método le siguieron otros y la lista de cristales artificiales se fue ampliando.
Hay que decir que aunque la síntesis de gemas es quizás el resultado más espectacular de estos procesos, el interés principal nunca fueron las gemas, sino obtener nuevos materiales con propiedades específicas, útiles para la industria. Incluso, el rubí de la primera vez no fue el resultado de un ambicioso intento "alquímico" de convertir un polvo blanco en una piedra preciosa. La intención fue otra; el rubí es capaz de producir el rayo láser, de gran importancia estratégica y comercial, y lo que se buscaba era un cristal de rubí grande, puro y libre de defectos, capaz de producir el preciado rayo, un cristal que la naturaleza no podía ofrecer.
En cualquier caso, independientemente del interés que haya podido conducir a ello, la lista de gemas sintéticas obtenidas es muy larga, algunas son la réplica exacta de sus equivalentes naturales, misma composición, misma estructura, mismas propiedades, todo igual.

Fig. 1. Rubíes y zafiros sintetizados por el método Verneuil (4-6 cm). Museo de la Geología (UCM). Foto V. López-Acevedo.
Hay esmeraldas, cuarzos, rubíes, zafiros… hasta diamantes. Otras sin embargo no tienen equivalente natural, aunque tienen cualidades que las hacen interesantes desde el punto de vista gemológico. Ejemplos de estas son algunas imitaciones del diamante como la conocida circonita. Esta se fabrica con todos los colores imaginables y constituye un nuevo material, muy bello y muy apreciado por joyeros y orfebres.
Otra aplicación directa de la Cristalografía al mundo de las gemas son las técnicas de identificación que aprovechan hasta el más mínimo rasgo de su estructura para reconocerlas. Aparatos muy sencillos e ingeniosos, algunos muy arcaicos aunque de comprobada utilidad, que permiten determinar constantes y comportamientos característicos. Lupas y pequeños artefactos ópticos que amplían la visión y nos muestran "todo", desde las huellas del proceso de cristalización que nos indican si la gema que tenemos delante es el resultado de un proceso natural o del trabajo en un laboratorio hasta su interior más profundo, defectos, fracturas, inclusiones… que nos llevan no solo a diferenciarlas sino a determinar su calidad e incluso su precio.
Esta rápida visión de la Gemología da idea de ese carácter exclusivo que comenté al principio. Un mundo al alcance de unos pocos que sin embargo puede mover enormes sumas de dinero y que requiere buenos especialistas conocedores de la materia para poder existir. Tasadores que determinen el precio de una joya, ya sea para adquirirla como inversión en épocas de opulencia o para venderla en épocas de crisis, expertos capaces de reconocer y valorar la calidad de una gema para su venta a joyeros y comerciantes, talladores que les den forma, artistas que diseñen las joyas, orfebres que las realicen,… profesores que enseñen estos oficios… Hay pocos, tú puedes ser uno de ellos.
Victoria López-Acevedo
Doctor en Ciencias Geológicas; Profesora de Departamento de Cristalografía y Mineralogía; Directora del Museo de la Geología; Facultad de Ciencias Geológicas. Universidad Complutense de Madrid.
Yo quiero ser genético molecular de plantas. En mi caso esta afirmación fue más un punto de llegada que un arranque vital. Siempre me ha sorprendido conocer que algún artista o científico relevante sabía lo que quería ser de mayor a edades tan tempranas como los tres o cuatro años. Yo no lo sabía. Nací en una familia de químicos y de profesores por lo que pronto me familiaricé con el uso de batas blancas y con los olores a productos químicos cuando acompañaba a mi padre, algún domingo, al laboratorio de Química Inorgánica de la Facultad de Ciencias de la Universidad de Valencia. Allí pude observar a profesionales como el soplador de vidrio que fabricaba ad hoc los instrumentos para realizar las reacciones químicas de síntesis o de análisis de productos. Aquel era un mundo mágico. Estudié Ciencias Químicas y aunque yo entonces no lo sabía, resultó ser muy recomendable para investigar en Biología Molecular.
Los productos naturales obtenidos de las plantas llamaron mi atención y despertaron el interés por conocer cómo y porqué producían las plantas sustancias con propiedades tan interesantes como las del ácido salicílico. Estaba decidido, realicé el doctorado en el Instituto de Agroquímica y Tecnología de Alimentos (IATA) del CSIC investigando los cambios metabólicos producidos en los naranjos cuando los infectaba el virus de la tristeza. Tratamos de entender la biosíntesis de la callosa, un polisacárido que obtura los vasos floemáticos de los cítricos en respuesta a la infección. Como consecuencia de ello, los árboles siguen absorbiendo agua y nutrientes del suelo a través del xylema pero no pueden enviar las sustancias necesarias para el desarrollo de las propias raíces. Resultado fatal, los árboles se mueren. Aprendí mucha enzimología de la mano de Juan Carbonell, discípulo del bioquímico español Alberto Sols. Durante la Tesis también aprendí los fundamentos del método científico, cómo plantear hipótesis y cuestiones concretas que se puedan someter a experimentación, a realizar observaciones cuidadosas en condiciones que se puedan repetir por otros y que sirvan para su corroboración o refutación. Aprendí el valor de la duda, del cuestionamiento. También a evaluar la idoneidad del sistema experimental para responder con rigor a las cuestiones planteadas. Sobre todo aprendí que quería dedicar mi vida a la investigación del mundo de las plantas.
Trabajar con árboles a nivel bioquímico era complicado, así que seguí mi camino cambiando de sistema experimental y de problema. Me desplacé a la Montana State University para estudiar con Gary A. Strobel una enfermedad fúngica de la cebada causada por Rynchosporium secalis. El hongo patógeno producía toxinas que reconocían receptores en las membranas celulares de las hojas de la cebada causando lesiones que reducían las cosechas. De nuevo, aprendí mucha bioquímica y muchas técnicas de aislamiento de sustancias y el uso de materiales radiactivos en el estudio de las interacciones toxina receptor. Una dificultad del trabajo consistía en la capacidad de mutar que tenía el hongo patógeno mientras lo cultivábamos en el laboratorio. A esto se añadía que las distintas variedades de cebada modificaban su susceptibilidad al patógeno. Aprendí que los genomas de las plantas y de los patógenos son flexibles y cambiantes, de forma que el concepto de resistencia a una plaga era temporal. Entre las poblaciones de patógenos siempre se generaba una estirpe capaz de vencer la resistencia de la planta huésped.
Volví a España tras dos años en Estados Unidos y tras pasar por el Departamento de Bioquímica de la Facultad de Ciencias de la Universidad de Valencia me incorporé a la Unidad de Biología Molecular y Celular de Plantas del (IATA) en el CSIC en Valencia. Allí llamó mi atención un sistema experimental desarrollado por José Luis García Martínez para estudiar el control hormonal del desarrollo de frutos. Las flores emasculadas de la planta de guisante tratadas con giberelinas producían frutos partenocárpicos indistinguibles de los obtenidos por fertilización salvo por la ausencia de semillas. Me propuse comprender los mecanismos de control de la entrada de asimilados en los frutos ya que podría descubrir principios básicos de la productividad de las plantas. De nuevo realicé múltiples experimentos de carácter fisiológico y bioquímico. Recuerdo con especial emoción los que realicé junto a Siegfried Jahnke en la Universität Essen utilizando plantas intactas de guisante a las que suministrábamos CO2 marcado con C11, un isótopo de vida muy corta producido en el ciclotrón médico del Klinikum. Era el sistema experimental perfecto para estudios de fisiología. Las hojas de guisante incorporaban el CO2 y producían sacarosa marcada con C11 que se movía por la planta para nutrir sus distintas partes. Nosotros tratábamos los ovarios con hormonas y estudiábamos su efecto sobre la distribución de asimilados mediante detectores externos que medían la radiactividad en las partes de la planta que deseábamos. Al cabo de tan sólo dos horas la planta estaba libre de radiactividad y podíamos comenzar otro experimento: la misma planta podía servir de control de sí misma comparando los resultados con los del experimento siguiente.
A principios de la década de 1980 se había producido un descubrimiento que cambiaría por completo la forma de estudiar la biología de las plantas. Jeff Schell y Marc Van Montagu en Europa y Mary D. Chilton en Estados Unidos explicaron el mecanismo molecular por el que la bacteria Agrobacterium tumefaciens era capaz de transferir genes bacterianos al genoma de las plantas. Nacía la genética reversa. Disponiendo de genes aislados en el laboratorio era posible introducirlos en las plantas y desvelar su función observando los efectos que causaban. Decidí que quería aprender este abordaje experimental y me trasladé al Max Planck Institut für Züchtungsforschung de Köln para trabajar con Heinz Saedler, Hans Sommer y Zsusanna Schwarz-Sommer en genética molecular del desarrollo floral. Abordamos el estudio de un mutante homeótico floral de Antirrhinum majus denominado Deficiens que desarrollaba sépalos en lugar de pétalos y carpelos en lugar de estambres. Era increíble, la mutación en un sólo gen provocaba esos cambios de identidad tan drásticos. Disponíamos de una serie alélica, fundamental para facilitar el análisis genético y en la planta había elementos transponibles activos que permitían el etiquetado de genes. No fue fácil.
Tras más de un año de experimentación extenuante conservo el recuerdo de la noche, cuando ya de madrugada, me di cuenta de que había realizado el experimento fundamental y tenía la prueba de que habíamos aislado el gen Deficiens. Es difícil explicar la emoción que sentí: me veo dando saltos de alegría en el laboratorio, sentía un hormigueo especial en los dedos. Estaba solo y no pude marcharme a dormir, esperé hasta que llegaron mis compañeros por la mañana para enseñarles los resultados y discutirlos. Fue maravilloso. Nuestro trabajo supuso, como reconocería la revista Nature, el comienzo de un nuevo campo científico, la genética molecular de las mutaciones homeóticas del desarrollo floral, que muy pronto daría lugar al conocido modelo ABC tras la incorporación al estudio del sistema experimental basado en Arabidopsis thaliana. A mí regreso a España, tras dos años, dediqué mi laboratorio al análisis genético y molecular del desarrollo floral en leguminosas campo en el que nos hemos convertido en un laboratorio de referencia internacional. Hemos aprendido mucho de duplicaciones génicas y de evolución floral en leguminosas y también hemos desarrollado herramientas biotecnológicas que nos permiten producir cosechas híbridas, aumentar el número de flores o producir frutos sin semillas. Actualmente estamos centrados en descubrir cómo producir más a partir de las plantas utilizando menos recursos y en condiciones ambientales desfavorables. Apasionante, quién me lo iba a decir cuando terminé mis estudios de Química.
Todo ha sido posible porque he tenido grandes maestros y grandes discípulos.
José Pío Beltrán Porter
Doctor en Ciencias Químicas
Profesor de Investigación del CSIC, Instituto de Biología Molecular y Celular de Plantas (IBMCP UPV-CSIC), Valencia.
A mediados del siglo XIX, Gregor Mendel estableció las leyes de la herencia de caracteres con sencillos experimentos usando guisantes. Casi un siglo después, en 1944, Oswald T. Avery, Colin McLeod y Maclyn McCarty aislaron el DNA como material genético, determinando así que el DNA es la molécula crucial de la herencia. Una década más tarde, Jim Watson, Francis Crick y Rosalind Franklin describieron la estructura de doble hélice del DNA y en 1961, finalmente se concluyó que el código genético se ordena por tripletes, gracias al trabajo de varios investigadores: George Gamow postuló que el código genético estaba formado por tripletes de bases nitrogenadas (adenina, timina, citosina, guanina) a partir de las que se formaban los veinte aminoácidos constituyentes de las proteínas; Marshall Nirenberg y su equipo publicaron en 1961 la primera asociación entre codón de triplete de bases y aminoácido. Trabajo que fue continuado por otros investigadores gracias a los cuales, se establece cómo a partir de cuatro bases nitrogenadas se construye el código genético, y a partir de éste, somos capaces de entender cómo alteraciones de estas bases modifican la secuencia de un gen y pueden causar enfermedades humanas. La fascinación que me produjo descubrir y entender cómo el cambio de una base por otra, algo tan minúsculo, puede producir que una persona padezca una enfermedad, determinó que yo sea genetista.
En este sentido, y también debido a las oportunidades que la vida te da, siempre me interesó entender el porqué de las enfermedades monogénicas. A grandes rasgos, podemos considerar dos tipos de herencia: herencia compleja o poligénica y herencia mendeliana o monogénica. En el primer caso, el resultado viene condicionado por una combinación concreta de cambios en el genoma más o menos complejos, cuando estas variantes del DNA de forma aislada no parecen contribuir al desarrollo de un rasgo específico. Pertenecen a este tipo de herencia rasgos tales como la altura, y la mayoría de enfermedades comunes como por ejemplo, la celiaquía o la enfermedad de Alzheimer. En cambio, un carácter mendeliano viene establecido por un único gen y éste podría resultar defectuoso sencillamente porque en un punto concreto de su secuencia se produce una mutación y por ejemplo, una adenina pasa a ser una guanina, modificando el código correcto de la secuencia de aminoácidos (Fig. 1).

Fig. 1. La mutación de una única base en la secuencia de DNA puede conducir al desarrollo de una enfermedad monogénica. Dibujo amablemente cedido por Julia Sánchez González.
Y sólo ese cambio, esa mutación, puede hacer que un niño nazca con una grave enfermedad neurodegenerativa. Así, es un rasgo monogénico con herencia dominante la capacidad para poner la lengua en forma de U, y pertenecen a este tipo de herencia la gran mayoría de enfermedades raras, entre las que encontramos la enfermedad de Wilson o cada una de las formas clínicas de la enfermedad con neurodegeneración con acumulación de hierro en cerebro (ENACH). Teniendo en cuenta que el genoma humano tiene un tamaño aproximado de 3.200 millones de pares de bases de DNA distribuidos en los 23 pares de cromosomas, y que contiene alrededor de 25.000 genes, al menos a mí no deja de sorprenderme que algunas mutaciones tengan unas consecuencias tan nefastas en una persona, privándole del desarrollo de una vida normal e incluso, ocasionándole la muerte a edad temprana. Y estamos hablando de una pequeña molécula que ha sido cambiada en una única posición de nuestro genoma que por otro lado, es inmenso.
Identificar la mutación que produce una enfermedad es sinónimo de determinar con exactitud cuál es la causa de la enfermedad. El diagnóstico genético es definitivo y certero. Pese a que en muchas ocasiones, ello no implique la cura del paciente, ni tan siquiera la aplicación de un tratamiento específico para la enfermedad, el hecho de poner nombre y apellidos al cuadro clínico que padece el paciente puede significar mucho. Hay que tener en cuenta que mayoritariamente las enfermedades monogénicas son raras y lograr para uno de estos pacientes el diagnóstico puede suponer un periplo de años, con el desánimo que supone ver cómo la enfermedad progresa y ni siquiera se sabe de qué afectación se trata. Saber con certeza qué enfermedad se padece, al menos debiera permitir conocer cuál va a ser la evolución de ésta y establecer una terapia, aunque sea meramente paliativa. Además, permite el consejo genético para familiares, la detección de individuos portadores y asintomáticos, y con ello posibilita una mejor planificación de la vida familiar (Fig. 2).
Como ya comenté la gran mayoría de enfermedades raras son mendelianas. El adjetivo "rara" viene principalmente condicionado por la prevalencia: en Europa se dice que una enfermedad es rara cuando afecta a menos de 1 en 2.000 individuos. Son pues, alrededor de 30.000.000 de ciudadanos europeos quienes sufren una de estas patologías. Además, se trata de enfermedades sobre todo pediátricas; en tanto que genéticas, son crónicas; y habitualmente muy discapacitantes, por lo que la calidad del enfermo se ve dramáticamente afectada. Se estima que hay más de 7.000 enfermedades raras. En la base de datos OMIM (Online Mendelian Inheritance in Man), que es un catálogo de patologías humanas mendelianas, se describen más de 15.000 genes implicados o que podrían estar implicados en el desarrollo de una enfermedad.

Fig. 2. Árbol genealógico de una familia con tres generaciones, que muestra que dos de sus miembros varones están afectados (cuadrados en negro; la flecha indica el caso índice, el primer diagnosticado). El resto de miembros están sanos o se desconoce su estatus (símbolos con el interrogante). El análisis de la mutación aclarará si están sanos o no
Fenotipos clínicos con el gen conocido se incluyen poco más de 5.000, y cada día en las revistas científicas se describen nuevas formas clínicas a la par que genes conocidos se asocian a nuevos cuadros patológicos. En suma, conforme entendemos mejor las bases moleculares de las enfermedades genéticas, nos damos cuenta de que el escenario es mucho más complicado de lo que pudiéramos sospechar. A esto hay que añadir que el número de pacientes es escaso por lo que es difícil definir las manifestaciones clínicas de cada enfermedad y con ello, es también complicado anticiparse a la progresión de la misma. Por todo ello, no veo otra solución que seguir trabajando para lograr desentrañar cuál es la genética de estas patologías, determinando exactamente cuál es el mecanismo molecular que las produce para lograr en un futuro una terapia para estos pacientes.
Aunque sea frase manida, es completamente cierto que trabajar en el umbral del conocimiento es pura adrenalina. Lograr el diagnóstico genético en un paciente afectado por una enfermedad rara puede ser más o menos costoso, en función de cuánto sepamos de la enfermedad, tanto desde el punto de vista clínico como del genético. Cuando estudias algún paciente y sus familiares con todas las herramientas tecnológicas existentes desarrolladas para el diagnóstico genético que puedes aplicar, yendo paso a paso, desde la secuenciación de un único gen candidato, pasando por un panel de genes que te permite el análisis de cientos de genes en una sola aproximación, hasta la secuenciación de su exoma (aproximadamente el 2% del genoma que corresponde a los genes codificantes de proteínas), y finalmente, consigues el diagnóstico genético tan perseguido durante muchos días/meses/años de dedicación, sencillamente es un momento de gran satisfacción. Si con este diagnóstico se logra el descubrimiento de un nuevo gen implicado en patología humana, es ya un hecho extraordinario por el que merece continuar dedicándose a esta profesión. No hay que olvidar que por el camino, hasta alcanzar este hito, se dejaron muchas cosas de lado, sacrificando la vida personal. Pero vale la pena.
Como suele suceder la consecución de hallazgos científicos abre nuevos interrogantes. Al descubrir un nuevo gen, al establecer cuál es la causa genética de una enfermedad, siempre surgen dos preguntas: ¿qué función tiene alterada este gen que hace que cause la patología?, y ¿qué papel juega este gen en la biología de la célula para explicar el fenotipo clínico observado? Y con ello, el trabajo empieza de nuevo. Enfrente de nosotros tenemos un paisaje desconocido en mayor o menor medida, en el que profundizar para responder a las dos cuestiones planteadas. Por ello, es importante continuar trabajando. Sólo si logramos las respuestas podremos entender con exactitud cuál es la fisiopatología de la enfermedad y a partir de ello, investigar para lograr una cura. Se estima que alrededor de 4.000 enfermedades raras carecen de cura. Son demasiadas entidades clínicas pendientes de ser resueltas, y detrás de ellas, hay personas, muchas veces niños, que esperan nuestros resultados. No hay que olvidar que al tratarse de enfermedades monogénicas lograr un tratamiento debiera ser más fácil porque sólo un gen es el defectuoso. Económicamente no interesa demasiado porque son pocos los pacientes afectados por cada una de ellas. De ahí la necesidad de investigadores que vocacionalmente, con mucho empeño y dedicación, nos volcamos en completar el puzle de los genes implicados en patologías humanas, con el propósito de lograr soluciones que mejoren la calidad de vida de tantos millones de enfermos en el mundo. Indudablemente, la dedicación y el esfuerzo compensan.
Carmen Espinós Armero
Doctora en Ciencias Biológicas
Investigadora Jefa de la Unidad de Genética y Genómica de Enfermedades Neuromusculares y Neurodegenerativas, Centro de Investigación Príncipe Felipe (CIPF), Valencia.
Directora Científica del Servicio de Genómica y Genética Traslacional, Centro de Investigación Príncipe Felipe (CIPF), Valencia.
Sé de la inexistente o, en el mejor de los casos, mala fama de la que disfruta la geología. Por eso, a los pocos valientes que estén dispuestos a leer este capítulo prometo no aburrirles. Sólo pretendo transmitir lo que la geología representa para mí, no simplemente una ciencia, sino mi gran pasión. Para empezar, enumeraré las razones que pueden llevar a afirmar con rotundidad: "quiero ser… geóloga"
Quiero ser geóloga para:
- Entender cómo ser formaron las montañas de mi alrededor.
- Entender los lentos, pero a veces catastróficos procesos que moldean la Tierra y relacionarlos con los ocurridos en el pasado.
- Encontrar los fallos en las películas de desastres naturales en las que tantas veces los protagonistas son geólogos.
- Considerar los peligros naturales a los que está expuesta mi casa y mi pueblo/ciudad.
- Identificar como en cualquier equipo de exploración, en la Tierra o en cualquier otro cuerpo celeste, por ejemplo, en la Luna, se necesita como mínimo un/a geólogo/a.
- Viajar al interior de volcanes activos y oler el azufre que tiñe todo de color amarillo.
- Bañarme en lagos en el interior de cráteres de volcanes inactivos.
- Tocar al mismo tiempo dos placas litosféricas separadas por una falla.
- Poner cada pie en la cuenca de drenaje de un océano diferente.
- Observar fascinada como mi sombra varía a lo largo del año y no solo a lo largo del día, y entender cómo eso tiene una incidencia en los relojes de Sol.
- Navegar por encima de fosas abisales o someras plataformas marinas, entendiendo que la fauna que habita en cada uno de estos contextos es muy distinta.
- Escalar calizas, areniscas o granitos, y no solamente piedras.
- Tumbarme en playas constituidas por millones de fragmentos de coral y otros muchos esqueletos de organismos.
- Comparar mi huella con la de un dinosaurio y transportarme a su hábitat, de clima, relieve y vegetación distintos.
- Valorar la complicada y casual existencia del ser humano.
- Adquirir perspectiva del tiempo.
- Tomar consciencia de que la mayoría de objetos manufacturados por los humanos han sido y son confeccionados a partir de los materiales de la Tierra, desde las piedras cortantes de los primeros homínidos a los ordenadores más avanzados, y que sin ellos no habría la tecnología que hay actualmente.
- Tener claro que todas las acciones antrópicas tienen sus consecuencias en la Tierra y, por lo tanto, para el resto de seres vivos con los que convivimos.
- Usar el agua teniendo en cuenta su delicado ciclo de evaporación y precipitación.
- Calcular el volumen de roca que se tiene que explotar para extraer el petróleo necesario para llenar el depósito de gasolina.
- Degustar frutas y verduras de sabores distintos según el suelo donde hayan crecido.
- Hacer campañas de campo con mis compañeros durante días disfrutando a partes iguales del trabajo y de la compañía.
Todas estas y muchas más razones son las que me harían repetir sin titubear la decisión que tomé hace años en matricularme a la facultad para cursar esta tan olvidada ciencia: la geología. Lo mejor de todo es que puedo decir que tomé la decisión sin saber ni la mitad de estas razones. Su descubrimiento progresivo a lo largo de los años sigue siendo emocionante hoy en día.

Fig. 1. Fragmentos de coral en la playa de Gili Trawangan (Indonesia).
Sinceramente, cuando me matriculé no tenía ni la más remota idea de qué me esperaba. Me llamaban mucho la atención las ciencias, pero a la vez no era capaz de decidirme por ninguna, porque cuando me miraba los planes de estudio me parecían muy monótonos, parecía que las asignaturas fueran extremadamente repetitivas. Cuando, por casualidad, comprobé el de geología, me sorprendió gratamente, ya que incluía asignaturas de física, química, matemáticas, biología, informática y otras muchas relacionadas con la geología. Y además estaban programadas numerosas salidas de campo, a la montaña, al mar, y no sólo por los alrededores de casa. Esto último recuerdo que causaba una clara envidia a mis amigos que estudiaban otras cosas. A finales de trimestre en vez de estar encerrada en la biblioteca, pasaba semanas fuera de casa.
No engañaré a nadie. A pesar de que la esté presentando de una forma desenfadada, que la geología no sea una ciencia exacta, no quiere decir que sea sencilla, todo lo contrario. Como en la mayoría del conocimiento, cuanto más se sepa, más cerca se estará de la verdad. Así, durante los primeros años de carrera se presenta el conocimiento fragmentado, a veces en forma de asignaturas nada motivadoras (como en el resto de estudios, la verdad). Esta metodología a veces puede ser desalentadora, pero al final llega un día maravilloso.
El día en que te das cuenta que eres capaz de relacionar todos esos conocimientos discretos, haciendo que converjan y tomen sentido. Ese día puede llegar durante los últimos cursos o más adelante durante los primeros trabajos. Ese día en el que pasas de asistir al campo para analizar elementos o procesos concretos, y pasas a analizar los estratos, las formas y los detalles como parte de un todo, sin clasificarlos en libros o apuntes de una asignatura concreta. Ese día en que sabes que te has convertido en geóloga, y que tu vida no volverá a ser la misma.
Y es que yo ya no recuerdo cómo era andar por la montaña o cerca del mar, o viajar en coche cruzando parajes sin observar e identificar todos los elementos que me llevasen a reconstruir ambientes, procesos, cambios, y en definitiva la historia geológica de lo que me rodea, de lo que nos rodea. Y cuando digo rodear, me refiero tridimensionalmente, incluyendo el interior de la Tierra y la tan necesaria atmósfera. No, no recuerdo cómo era observar la naturaleza sin entenderla, sin apasionarme, sin querer compartir la belleza del saber con los que me acompañan. En definitiva, ¡sin divertirme!
Al principio, además, los profesores nos repetían que estudiar geología nos abriría las puertas a viajar mucho. Yo no lo entendía y tampoco le daba demasiada importancia. Con el tiempo, definitivamente, ha sido uno de los puntos fuertes de mi formación. No sólo durante la carrera y durante mi vida profesional, sino que en escoger un destino de vacaciones priorizo su contexto geológico. Disfruto de los volcanes y de las formaciones rocosas tan distintas a las de la Península Ibérica y de los paisajes que alcanzan hasta más allá de donde alcanza mi vista.
Con todo esto quiero llegar a explicar que ser geóloga no se limita a coleccionar rocas y minerales en cajitas. Ser geóloga es ser la criminóloga de la naturaleza, donde unas evidencias bien escogidas permiten acercarse a la verdad, a descubrir qué es lo que se esconde en el puzle de tantos millones de piezas.
Actualmente soy profesora de instituto y sé que un porcentaje diminuto de mis alumnos se convertirá en geológos/as.

Fig. 2. Lago en el cráter del volcán Cerro Chato (Costa Rica).
Mi objetivo tampoco es ese. Me conformaré con que sepan apreciar la naturaleza y con que se formen un rico espíritu científico. Pero quizás después de estas líneas sí que te he convencido a ti, paciente y valiente lector/a.
Marta Ferrater Gómez
Licenciada en Geología y Doctora en Ciencias de la Tierra
Cuando era niño recuerdo que me encantaban los documentales y los libros que te trasladaban a mundos donde solamente los grandes exploradores llegaban. Así, desarrollé cierta afición por la fotografía de la naturaleza.

Fig. 1. Corte sagital de la Imagen de un ratón de laboratorio tomada por un equipo multimodal PET/CT para animales pequeños. CT, imagen estructural basada en la atenuación de los rayos X en los tejidos. PET, imagen funcional basada en la captación de 18F-FDG. PET/CT, fusión de ambas técnicas dando una imagen donde podemos localizar con precisión los tejidos que han captado 18F-FDG.
Más tarde, en mi periplo profesional, descubriría que esos mundos tan extraordinarios que fotografiar y documentar no están solo ahí fuera ¡Sino dentro de nosotros! Que más allá de la luz visible, hay otras ondas electromagnéticas con distintas propiedades que nos dejan ver el interior de los organismos. Estas herramientas no solo nos permiten describir cómo son las estructuras biológicas sino también entender cómo funcionan.
¿Qué es la imagen biomédica?
La imagen biomédica es la ciencia y rama de la medicina interesada en el desarrollo y uso de aparatos y técnicas para obtener imágenes de la anatomía interna y en proveer un análisis bioquímico y fisiológico de tejidos y órganos. En este campo colaboran profesionales de muchos ámbitos como, por ejemplo: físicos, ingenieros (telecomunicaciones, electrónicos, informáticos o bioingenieros), matemáticos, radiofarmacéuticos, radioquímicos, médicos, etc.… ¿Cómo he llegado yo aquí? En mi caso, con formación en biología, estoy interesado en el desarrollo de sondas moleculares (moléculas muy afines a otras moléculas o procesos fisiológicos) que puedan ser monitorizadas por estas técnicas para entender cómo funciona la fisiología humana en condiciones de salud y enfermedad. Las técnicas de imagen biomédica se pueden clasificar en dos grandes grupos: las estructurales y las funcionales. Las técnicas del primer grupo nos dan información sobre la anatomía y la composición del organismo de estudio. Algunos de los ejemplos más conocidos son la radiografía, la tomografía axial computarizada (TAC o CT, en inglés), los ultrasonidos o la imagen por resonancia magnética (IRM o MRI, en inglés). Por otro lado, las técnicas funcionales y moleculares nos informan sobre los diferentes procesos metabólicos que están ocurriendo en nuestro sujeto de estudio, en este caso por su relevancia clínica, las más interesantes son la tomografía por emisión de fotón único (TCEFU o SPECT, en inglés) y la tomografía por emisión de positrones (TEP o PET, en inglés). Todas estas herramientas se utilizan actualmente en los hospitales para visualizar el interior de los pacientes y diagnosticar muchos tipos de enfermedades, desde una pierna rota hasta el cáncer o el Alzheimer. Además, las técnicas de imagen, estructurales y funcionales, se pueden unir en lo que se conoce como equipos multimodales e híbridos. Estos sistemas, como el PET/CT, nos dan imágenes con una información más útil y completa. Como una imagen vale más que mil palabras y este capítulo trata de imágenes, en la Fig. 1, podemos ver un ratón de laboratorio "fotografiado" mediante dos técnicas de imagen diferentes, estructural (CT) y funcional (PET), y ambas fusionadas ya que fueron tomadas del mismo animal en un equipo multimodal (PET/CT). En la imagen estructural tomada por CT vemos la radiodensidad de los diferentes tejidos, esto es, la capacidad que tienen de atenuar los rayos X. Los tejidos más opacos a los rayos X son los huesos, apareciendo en blanco, mientras los órganos como los pulmones, formados por aire, son transparentes, por ello aparecen en negro. En la imagen funcional de la PET vemos unas manchas que representan la captación de glucosa en los tejidos y órganos. Para poder ver su distribución, a este azúcar se le ha introducido el átomo radiactivo de un elemento químico (radioisótopo), en este caso flúor-18 (18F), por esto se le conoce como 18F-Fluorodesoxiglucosa (18F-FDG). Esta situación permite al escáner PET detectar las fuentes de emisión de radiactividad dentro del organismo. En la imagen vemos que el órgano que más 18F-FDG capta es el musculo del miocardio en el corazón (la forma de U en la imagen es debido a las aurículas y ventrículos), además hay otros tejidos en los que también vemos una captación considerable de 18F-FDG como son el cerebro, la grasa parda, las glándulas harderianas y los riñones. En los hospitales, la evaluación de la captación de 18F-FDG es utilizada frecuentemente en las áreas de oncología, neurología y cardiología.
Localizando el cáncer
Como investigador en imagen biomédica, utilizo la PET/CT para monitorizar moléculas afines a algunas características que solamente poseen los tumores. De esta manera, podemos intentar mejorar o complementar las actuales herramientas de diagnóstico en oncología. En concreto, la investigación en la que he colaborado junto con mis compañeros de la Unidad de Aplicaciones de Radioisótopos del Centro de Investigaciones Energéticas, Medio Ambientales y Tecnológicas (CIEMAT) en colaboración con otros científicos del Centro Nacional de Investigaciones Oncológicas (CNIO) y del Centro Nacional de Investigaciones Cardiológicas (CNIC) ha tratado del desarrollo de una sonda molecular para la detección de una proteína transmembrana (MT1-MMP) que se sobreexpresa en las células de algunos tipos de cáncer como el glioblastoma, el más mortal de los tumores cerebrales en adultos.

Fig. 2. Corte axial (izquierda) y sagital (derecha) de una imagen PET/CT de un ratón portador de un tumor cerebral (flecha) detectado por un anticuerpo marcado con un radioisótopo que se une a una proteína que es sobre expresada por este tipo de cáncer. El hígado es la principal vía de metabolización de los anticuerpos radiomarcados (rojo).
Para su desarrollo hemos utilizado un anticuerpo, específico para MT1-MMP, y lo hemos marcado con un radioisótopo del zirconio (zirconio-89) para detectarlo por PET. Este enfoque en el que se utilizan anticuerpos (también llamados inmunoglobulinas) y la técnica de imagen PET se conoce como inmunoPET. En la Fig. 2, podemos ver la ubicación de un tumor, formado por una línea celular de glioblastoma humana, en un roedor gracias al anticuerpo específico para MT1-MMP que hemos desarrollado. Además del tumor, el órgano que más capta nuestro anticuerpo es el hígado del ratón ya que es la vía por la que estas macromoléculas se metabolizan.
Un poco más de imagen
Por último, no quiero despedir el capítulo sin poner otros ejemplos de imagen biomédica para que tengas una mayor perspectiva de estas herramientas que nos ayudan a "fotografiar los paisajes internos del organismo".

Fig. 3. Captación de 18F-FDG antes(a) y después(b) de un tratamiento por inmunoterapia en un paciente de cáncer de pulmón de células no pequeñas con metástasis. Extraído de Mitsunori Higuchi et al. (2016).
Por ello, he buscado tres aplicaciones diferentes en revistas científicas.
-Además del diagnóstico, la18F-FDG se puede utilizar en la monitorización de los tratamientos oncológicos como la inmunoterapia (Fig. 3). Como podemos ver en la imagen, los focos de captación de la glucosa son los tumores (efecto Warburg) que tras la inmunoterapia han reducido su tamaño conside-rablemente.
-El uso de las técnicas de imagen y la moderna impresión 3D puede ofrecernos la posibilidad de realizar útiles modelos anatómicos para la enseñanza o el entrena-miento de personal médico ¡Imprime tus propias costillas, hígado y pulmones! (Fig. 4).

Fig. 4. Pasos para transformar los datos de imagen de un CT en un modelo anatómico imprimible por una impresora 3D. Extraído de Bücking TM et al. (2017).
-Las técnicas de imagen aplicadas al sistema nervioso central, neuroimagen, nos pueden ayudar en el diagnóstico y evaluación de la progresión de enfermedades como el Parkinson (Fig. 5).

Fig. 5. Imágenes PET con 18F-FDG y MRI en un paciente con la enfermedad de Parkinson y deterioro cognitivo. En esta imagen se puede observar un déficit del metabolismo de la glucosa y una reducción del volumen en el hemisferio cerebral izquierdo. Las imágenes A1-4 representan la reconstrucción 3D de la captación de 18F-DG en el cerebro. Las imágenes B, C y D son diferentes modos de imagen PET/MRI fusionadas. Extraído de TaiseVitor et al (2017).
Conclusión
La imagen biomédica es una herramienta muy potente para "fotografiar" el interior de los seres vivos y ayudar a los médicos a entender mejor las enfermedades. Es un campo en el que se puede aportar desde muchas profesiones y que está en constante crecimiento.
¡Ayúdanos a descubrir los intrincados misterios del cuerpo humano!
Referencias:
[1] de Lucas AG, Schuhmacher AJ, Oteo M, Romero E, Cámara JA, de Martino A, et al. Targeting MT1-MMP as an ImmunoPET-Based Strategy for Imaging Gliomas. PLOS ONE (2016).
[2] Mitsunori Higuchi, Yuki Owada, Takuya Inoue, Yuzuru Watanabe, Takumi Yamaura, Mitsuro Fukuhara, et al.FDG-PET in the evaluation of response to nivolumab in recurrent non-small-cell lung cancer. World J SurgOncol. 2016; 14(1): 238.
[3] Bücking TM, Hill ER, Robertson JL, Maneas E, Plumb AA, Nikitichev DI. From medical imaging data to 3D printed anatomical models. PLOS ONE (2017).
[4] TaiseVitor et al (2017).TaiseVitor, KarineMinaifMartins, Tudor MihaiIonescu, Marcelo Livorsi da Cunha, Ronaldo HuebBaroni, Marcio Ricardo Taveira Garcia, et al. PET/MRI: a novel hybrid imaging technique. Major clinical indications and preliminary experience in Brazil. Einstein (Sao Paulo). 2017 Jan-Mar; 15(1): 115–118.
Ángel García de Lucas
Doctor en Biociencias Moleculares
Investigador de la Unidad de Aplicaciones de Radioisótopos, CIEMAT.
Decidí convertirme en investigadora el día que fui de excursión escolar a una fábrica de yogures con 9 años de edad. Cuando llegamos, nos pusieron batas blancas a todos y nos llevaron de visita por la planta, incluyendo distintos laboratorios. En ese momento, junto a las pipetas, me di cuenta de que lo que yo quería saber era cómo funcionaba todo. Imaginaba nuestro cuerpo por dentro, y poco a poco fui desarrollando interés por lo que es la ciencia y qué mecanismos son los responsables de que estemos sanos o desarrollemos una enfermedad.
A pesar de que la medicina avanza muy rápidamente y la cura de un gran número de enfermedades está a la vista y que nuestra perspectiva de vida pronto se acercará a los 100 años, todo eso no será posible si no existe de forma paralela un avance en la investigación biomédica. Es necesario conocer los mecanismos que regulan el funcionamiento de nuestras células, órganos y tejidos, y por qué si un gen deja de funcionar o se muta, esto puede afectar a nuestro organismo de forma global provocando tumores, fallo en órganos, o una enfermedad neurodegenerativa.
En la actualidad existen un gran número de recursos y técnicas, organismos modelo (levadura, mosca, pez cebra, o ratones) y líneas celulares de laboratorio que nos permiten investigar e imitar lo que pasa en el cuerpo humano, y de esta forma hallar las respuesta que vamos buscando, por qué envejecemos o por qué enfermamos, por ejemplo. El abordaje de la investigación biomédica se puede realizar desde múltiples perspectivas y todas son válidas, microbiología, inmunología, histoquímica, bioquímica, biología molecular, bioinformática, y además se pueden integrar todas para conseguir responder a las preguntas que se nos planteen. La integración de todas estas disciplinas dará lugar a una mejor respuesta.
La búsqueda de respuestas, en mi caso, me llevó en primer lugar a licenciarme en Farmacia y luego realizar mi tesis doctoral en microbiología estudiando los procesos que hacen de un hongo que en teoría solo provoca infecciones de forma ocasional (Candida albicans) se pueda convertir en algo letal para el cuerpo humano, convirtiéndose en uno de los principales agentes de infecciones nosocomiales (infecciones que tienen lugar cuando los pacientes están ingresados en hospitales por otras causas). De esta manera, estudiando el hongo, y utilizando técnicas de bioquímica (estudiando proteínas), biología molecular (estudiando los ácidos nucleicos, el DNA, RNA) y con ayuda de microscopios y las primeras herramientas bioinformáticas, conseguí caracterizar un gen implicado en la virulencia de Candida albicans y que sirvió además como diagnóstico en pacientes infectados (Fig. 1).

Fig. 1. Observación al microscopio del hongo patógeno oportunista Candida albicans, y de su apariencia en medio de cultivo.
Posteriormente, en mi fase postdoctoral, cambié a un campo emergente y fascinante como es el de las células madre. Las células madre son un conjunto de células con elevada capacidad de autorrenovación y diferenciación y se clasifican en función de su origen. Las células madre adultas son un número reducido de células que se encuentran en nuestros órganos y tejidos y son responsables de reemplazar aquellas células dañadas que se pierden cada día, como aquellas en nuestra piel, pelo, sangre o intestino, o que se activan en respuesta a un daño agudo o crónico como ocurre en el hígado. Estas células madre adultas tienen capacidad de renovarse y diferenciarse de forma limitada, normalmente dentro de su linaje celular. Por otro lado, se encuentran las células madre embrionarias (hESC) que se derivan a partir de embriones excedentes de ciclos de reproducción asistida y que tienen capacidad de autorrenovarse y diferenciarse de forma ilimitada, es decir, son inmortales y con capacidad de diferenciarse en cualquier tipo de célula del organismo.

Fig. 2. Estrategia de derivación de células madre embrionarias humanas (hESC). Diferenciación a distintos tipos celulares.
Nuestro laboratorio fue el primero en derivar líneas hESC en España (Fig. 2), y conseguimos generar y caracterizar un buen número de líneas hESC de distintos estadios y características genéticas. Este modelo celular es excelente porque permite obtener células de hígado, piel o hueso, y además son un modelo excepcional para estudiar enfermedades, bien sean enfermedades causadas por un gen (monogénicas), o causadas por distintos agentes o procesos patológicos como puedan ser la diabetes, o el cáncer. La medicina regenerativa en un futuro podrá valerse de las células madre, tanto adultas como embrionarias, para un gran número de terapias, incluyendo trasplantes de piel en quemaduras, de órganos como hígado, páncreas o riñón (ya existen organoides obtenidos en placas de cultivo), regeneración de cartílago, o reversión de la ceguera como se está demostrando con los últimos experimentos y ensayos clínicos incipientes. A día de hoy, existen multitud de ensayos clínicos avanzados en curso para la aplicación de estas células en múltiples terapias.
Después de ese periodo, en la actualidad trabajo en el campo de la neuroendocrinología molecular, especialmente en el estudio de los efectos de la alteración del metabolismo de la insulina en el cerebro y el hígado, y fundamentalmente en la respuesta del hígado y de sus células progenitoras (células madre del hígado) frente a un daño crónico. La diabetes y la obesidad son enfermedades metabólicas con una prevalencia del 13% y 30% respectivamente en España. Estas dos patologías comparten una alteración en el metabolismo que resulta en la resistencia a insulina, y en una relación directa con el daño crónico en el hígado y el hepatocarcinoma, la tercera causa mortal de cáncer en el mundo. En nuestro laboratorio, hemos desarrollado un modelo celular in vitro que demuestra que la insulina es necesaria para el desarrollo normal y diferenciación de los hepatocitos (células del hígado), y que la resistencia a insulina mediada por el gen IRS2 puede inhibir este proceso, e igualmente estar relacionado con el daño crónico y la falta de respuesta en el hígado. Para poder abordar estas cuestiones contamos con numerosos estudios en líneas celulares y también con un modelo de ratón mutante (KO) para irs2 (irs2-/-) (Fig. 3). Los estudios de expresión génica, análisis de tejidos y proteínas están desvelando resultados muy prometedores en el papel de la resistencia a la insulina y el daño hepático crónico generando respuestas y esperanzas a nuevas soluciones terapéuticas.
Este es solo un pequeño enfoque de lo que los estudios en biomedicina pueden resultar. El mundo de la ciencia es maravilloso y fascinante.

Fig. 3. Diseño experimental para elucidar el papel de la resistencia a insulina en el daño hepático crónico y respuesta regenerativa in vivo e in vitro.
Cada día que pasa se descubren miles de cosas, y la mayoría nos pasan inadvertidas, pero nunca hay que dejar de preguntarnos por qué ocurren las cosas y cómo es posible que seamos tan complejos, y al mismo tiempo, funcionemos tan bien. El ser humano siempre busca respuestas y en el laboratorio tenemos las herramientas adecuadas, y a pesar de que el trabajo no siempre es satisfactorio, y que la paciencia y el tesón es fundamental, podemos encontrar soluciones a un amplio rango de cuestiones que nos planteemos, y conseguir un pequeño (ojalá gran) descubrimiento. Además, las puertas de la ciencia siempre están abiertas, se fomenta el diálogo, la discusión, el estudio, y el intercambio entre culturas y conocimientos de otros laboratorios en multitud de países. Así pues, el trabajo en ciencia, es una oportunidad que no debemos dejar escapar.
Esa niña de nueve años que una vez fui, hoy tiene más respuestas gracias a la investigación científica.
Amparo Galán Albiñana
Doctora en Farmacia
Investigadora. Laboratorio de neuroendocrinología molecular. Centro de Investigación Príncipe Felipe. Valencia
Profesora asociada. Departamento Bioquímica. Universidad de Valencia.
Cuando era estudiante de primero de BUP (Bachillerato Unificado Polivante), tuve uno de los mejores regalos que una adolescente puede tener: un profesor entusiasta que disfruta enseñando, en mi caso, mi profesora de ciencias naturales. Neus Lloveras había sido discípula de Rosa Sensat, una educadora catalana, que en las primeras décadas del siglo XX introdujo en España modernas teorías pedagógicas, como una escuela al aire libre (Escuela del Bosque).

Fig. 1. Esquema de la formación de un basidio, tras visualizar la película del ciclo reproductor de un basidiomicota. M.P.Martín, 3-11-1978.
Y, desde luego, en mi profesora todos notábamos, no sólo un profundo conocimiento de la materia, sino un estilo peculiar con el que nos transmitía la curiosidad por el mundo que nos rodeaba. Sin duda, fue ella la que puso la primera semilla para que germinara, más tarde, mi vocación científica. En el laboratorio del Instituto Torres i Bages de Hospitalet de Llobregat (Barcelona) realizábamos numerosas clases prácticas, muchas de ellas se repiten en la actualidad en las aulas de ESO. En las excursiones, llevábamos libretas y otros materiales ya que, en grupos, recopilábamos datos sobre la flora, la fauna o el suelo de una zona determinada. Después, cada grupo elaboraba, por ejemplo, un herbario, una colección de insectos, un mural, etc.; el trabajo final dependía de las habilidades individuales y de la interacción del grupo. Pasadas unas semanas, en el aula o en el patio del instituto, cuando hacia buen tiempo, exponíamos, aunque sin los medios audiovisuales actuales, de forma interactiva los trabajos. Para completar los temarios oficiales que, en muchas ocasiones, eran difíciles de digerir, en el aula veíamos documentales de la BBC. Los temas eran muy variopintos y, aunque no recuerdo los títulos exactos, no serían muy diferentes de "La vida de los calamares", "¿Qué son los hongos?", "El descubrimiento de la penicilina", o "La vida de Marie Curie". Sus clases eran sin duda enriquecedoras (Fig. 1). Con 15 años no sabía que sería científica, pero estaba segura de que quería ser bióloga. Más tarde, en la licenciatura me decanté por la rama de Botánica y, a través del libro Alexopoulus (1966) [1] y las diapositivas que el Prof. Xavier Llimona nos pasaba en las clases de Criptogamía empecé a descubrir el megadiverso mundo de los hongos. Me he especializado en micología, la ciencia que estudia los hongos, y mi investigación se centra en descubrir y describir su diversidad mediante caracteres morfológicos, fisiológicos y moleculares, analizar la variabilidad genética de las especies y establecer las relaciones filogenéticas entre ellas.
Pero, ¿qué son los hongos?
Una de las definiciones más completas sobre qué son los hongos se encuentra en Telleria (2011) [2]: "Los hongos son seres eucariotas y heterótrofos que se alimentan por absorción, se reproducen por esporas de origen tanto sexual como asexual y, por lo general, presentan estructuras somáticas filamentosas, provistas de paredes celulares; estructuras que, individualmente, llamamos hifas y, en su conjunto, micelio". Son eucarióticos, ya que sus células poseen núcleos verdaderos, donde están encerrados los cromosomas; lo que los diferencia de los procariotas, como las bacterias, cuyo ADN está disperso en el citoplasma; y son heterótrofos (del griego ἕτερος, heteros, "otro, desigual, diferente", y τροφή, trofo, "nutrición"), ya que se alimentan con las sustancias orgánicas sintetizadas por otros organismos, en contraste con los autótrofos, como las plantas, que sintetizan las sustancias esenciales para su organismo a partir de sustancias inorgánicas y una fuente de energía que suele ser la luz. Organismos eucarióticos y heterótrofos, además de los hongos, son los animales; sin embargo, mientras que los animales para nutrirnos, ingerimos primero y digerimos después, los hongos lo hacen al contrario: primero digieren el alimento en el medio externo mediante enzimas que liberan, y luego lo absorben a través de sus paredes y membranas celulares. Este modo de alimentación típico de los hongos se conoce como lisotrofia; y gracias a las enzimas los hongos pueden digerir moléculas complejas y prácticamente insolubles (carbohidratos, proteínas, lípidos, etc.) transformándolas en nutrientes simples y solubles. Antes del desarrollo de los análisis moleculares del ARN, se clasificaba a los hongos en el reino Vegetal, ya que producen esporas. Sin embargo, en la actualidad sabemos que son un grupo de organismos más cercanos al reino Animal que al de las plantas, y constituyen un grupo monofilético propio (comparten un ancestro común), el reino Fungi.
¿Por qué me especialicé en micología?
Los hongos presentan una gran y, muchas veces, sorprendente variabilidad morfológica, y esto, junto a las pocas especies que se conocen, unas 120.000 especies frente al millón y medio que se calcula existen en la tierra, fue lo que me atrajo de ellos. Es muy probable que los primeros hongos aparecieran antes que las primeras plantas terrestres, y más tarde se asociaran con ellas formando micorrizas (simbiosis entre las hifas de un hongo y las raíces de una planta). Con esta asociación, las plantas conseguían, como ahora, el agua y las sales minerales que les aportaba el hongo, lo que permitió su extensión en una Tierra, por aquella época todavía hostil. Al menos, así lo corroboran las hifas y esporas fosilizadas que se han encontrado en estratos de 460 millones de antigüedad (período Ordovícico) en Wisconsin (Redecker et al. 2000 [3]). En el Ordovícico, las plantas eran muy pequeñas, como Aglaophyton major que presentaba un rizoma (tallo subterráneo) del que sobresalían tallos aéreos de unos 15 cm de altura; es en fósiles de A. major dónde se han encontrado esporas e hifas que recuerdan a los Glomales, hongos actuales que forman micorrizas arbusculares con numerosas plantas. Aunque la clasificación de los hongos no es definitiva, se consideran 8 grupos monofiléticos (un ancestro común): 1) los Chytridiomycota son, en general, acuáticos y presentan esporas móviles, muchos son parásitos de plantas e insectos. La especie Batrachochytrium dendrobatidis es considerada una de las responsables del declive global de la población de anfibios; 2) los Neocallimastigomycota son anaerobios facultativos, no tienen mitocondrias sino hidrogenosomas, y viven, por ejemplo, en el aparato digestivo de los herbívoros; 3) los Blastoladiomycota son saprófitos o parásitos de algas y larvas de insectos; 4) los Microsporidia son unicelulares y parasitan animales; 5) los Zygomycota presentan unas hifas sin septos transversales (sifonadas), forman parte de los llamados mohos de crecimiento rápido, y unos grupos parasitan insectos y artrópodos; 6) los Glomeromycota que forman una simbiosis especial con raíces de plantas vasculares, las micorrizas de tipo arbuscular, en las que el hongo penetra en las células corticales de las raíces de las plantas; 7) los Ascomicotas, el grupo más amplio y diverso de hongos, entre los que se encuentran organismos microscópicos tan conocidos como Saccharomyces cerevisiae (la levadura de la cerveza) o el Penicillium notatum (hongo aislado por Fleming y del que se obtenía penicilina), y otros casi desconocidos parásitos de insectos (laboulbeniomicetes). A este grupo pertenecen también, por ejemplo, las preciadas trufas; y, 8) los Basidiomicotas, entre los que se encuentran las royas y los carbones, parásitos obligados de plantas vasculares, o las levaduras del género Malassezia, que causan una enfermedad de la piel denominada pitiarisis versicolor; también, numerosos hongos que producen basidiomas en forma de seta, algunas de ellas comestibles. Yo empecé estudiando un grupo de basidiomicotas cuyos cuerpos fructíferos (basidiomas), en general globosos cuando son jóvenes, tienen un desarrollo angiocárpico (permanecen cerrados hasta que maduran las esporas). Estos hongos se incluían en la clase Gasteromycetes. Sin embargo, los estudios moleculares han confirmado que la naturaleza angiocárpica ha surgido en numerosas ocasiones a lo largo de la evolución de los hongos, en distintos órdenes de Agaricomycotina (Agaricales, Boletales, Geastrales, Gomphales, Phallales, Russulales), por lo que no proceden de un antepasado común (grupo polifilético), y, por tanto, la clase Gasteromycetes, como clase artificial que es, está obsoleta. En la actualidad, nos referimos a estos basidiomicotas como "hongos gasteroides". Estos hongos presentan una gran diversidad de basidiomas y se considera que el tipo de desarrollo de estos hongos es una adaptación a climas áridos. En el Real Jardín Botánico-CSIC, formo parte del grupo de investigación que estudia los hongos corticioides, incluidos tradicionalmente en los Aphyllophorales s. auct., y en la actualidad en varios órdenes de Agaricomycetes (Basidiomycota), entre ellos, Atheliales, Boletales, Corticiales, Hymenochaetales y Trechisporales. Estos hongos son, como los gasteroides, un grupo artificial polifilético, ya que no proceden de un antepasado común; presentan la morfología de su basidioma resupinada o efuso-refleja, como una costra sobre el sustrato, y comparten un mismo nicho ecológico, la madera muerta en distintos grados de descomposición. Se conocen de todas las regiones del planeta, a excepción de los polos y se consideran organismos clave para interpretar la evolución de los basidiomicota. Como en otros hongos, la delimitación de sus especies se ha basado tradicionalmente en el análisis de caracteres de sus basidiomas (macro y micromorfológicos); sin embargo, con las herramientas moleculares se ha podido demostrar que especies de amplia distribución, corresponden a un complejo de varias especies crípticas (misma morfología), con rangos de distribución restringido. En el proyecto que estamos trabajando en los últimos años "El cosmopolistismo en hongos corticioides, una visión desde la América austral", queremos contestar a las siguientes preguntas ¿son los hongos corticioides australes mayoritariamente cosmopolitas como tradicionalmente se ha supuesto para este grupo de organismos?, o por el contrario, ¿están éstos sujetos a algunos de los patrones que rigen la distribución del resto de los organismos? Como los hongos corticioides del hemisferio norte están bastante bien estudiados, para contestar a estas preguntas lo primero que hemos hecho es muestrear en diversas zonas de Chile, así como obtener especímenes de diferentes herbarios mundiales. Ahora tenemos miles de muestras para estudiar, describir y darles un nombre (sistema binomial de nomenclatura). Estos datos nos ayudarán a comprender e interpretar los patrones que rigen la distribución de las especies en ambos hemisferios y a completar, con la descripción de especies nuevas, el catálogo de la vida.
¿Cómo descubrimos y describimos las especies?
Los micólogos, descubrimos y describimos las especies de hongos, mediante caracteres morfológicos, tanto macroscópicos (ej. forma, tamaño y color del basidioma y del himenio), como microscópicos (ej. forma y tamaño de los basidios, forma y tamaño de las esporas); y, desde la llegada de las herramientas moleculares, mediante el análisis de distintas regiones del genoma (ADN de un organismo).

Fig. 2. Arriba: Tomentella sublilacina y Tomentella ferruginea (Fotos: M.T. Telleria). Abajo: Un fragmento de las secuencias barcode de distintas especies de Tomentella (Foto: M.P. Martín). Fuente: El diario del Jardín Botánico 3: 10.
En particular, para la identificación de las especies, utilizamos la herramienta conocida como el código de barras de ADN, que se basa en confrontar el fragmento de ADN (barcode) de una muestra desconocida, con una o más secuencias de muestras bien identificadas; lo que permite la identificación rápida, para los investigadores que lo necesiten (Fig. 2). Cada especie se identifica por su ADN-barcode, de forma similar a como un código de barras de líneas negras permite identificar un producto determinado en un supermercado. Esta herramienta es especialmente útil, para la identificación de organismos poco visibles, o con pocos caracteres morfológicos para su identificación, tales como los hongos. En muchas ocasiones, en el sustrato (por ejemplo, suelo o restos vegetales) solo aparecen las partes vegetativas -las hifas, que forman el micelio-, que tienen un aspecto más o menos idéntico en el microscopio, por lo que no se puede llegar a conocer la especie solo por los caracteres morfológicos.
A modo de conclusión
Mis colegas micólogos verán que en estas breves páginas, no he reunido todos los temas que la micología abarca; sin embargo, espero que en algunos de los lectores más jóvenes haya surgido una chispa de curiosidad para acercarse a una ciencia que puede llevarles a explorar lugares exóticos o poco conocidos, como me ha llevado a mí, por ejemplo, a Brasil, a Cabo Verde, o a la Patagonia Chilena; o a aprender diferentes métodos de identificación (microscopía, técnicas de ADN, etc.), para seguir descubriendo y describiendo la diversidad de hongos. La micología es mucho más que recolectar en el campo setas (basidiomas) para consumir. ¡Descúbrela!
Referencias:
[1] Alexopoulos CJ. 1966. Introducción a la micología. Edt. EUDEBA, Buenos Aires. 615 pp.
[2] Telleria MT. 2011.Los hongos. Vol. 22 de ¿Qué sabemos de...? Editor CSIC, Consejo Superior de Investigaciones Científicas, 126 pp. ISBN 840009316X, ISBN 9788400093167
[3] Redecker D, Kodner R, Graham LE. 2000. Glomalean fungi from the Ordovician. Science 289: 1920 1921.
María P. Martín Esteban
Doctora en Botánica
Investigadora Científica de OPIs, Real Jardín Botánico, CSIC
Todos los días somos perjudicados o nos beneficiamos, directa o indirectamente, por hongos. ¡Los micólogos son las personas que estudian estos seres increíbles! Gracias a sus características, los hongos son indispensables para el planeta y están más presentes en tu día a día de lo que imaginas. Conocer estas propiedades es esencial para que entiendas la importancia de los hongos y por qué el trabajo de un micólogo es tan apasionante.

Fig. 1. río Tinto (Huelva)

Fig. 2. La microbiología estudia diversos organismos de tamaño microscópico y multitud de formas.

Fig. 3. Microbiota normal humana [3].



Fig. 1. Ejemplo de paneles bio-solares en la Vrije University, Ámsterdam.

Fig. 1. Fauna Ibérica. El hombre y la Tierra. Félix Rodríguez de la Fuente. (Crédito: De Richard Bartz, Munich aka Makro Freak - Trabajo propio, CC BY-SA 2.5, )

Fig. 2. Recreación artística del RNA. (Crédito: vossman wikipedia commons)


Fig. 1. Imagen de un hipocampo fluorescente.

Fig. 1. ¡Es la nueva biología molecular!

Fig. 2. Suicidio Celular.

Fig. 1. Yacimiento de la Gran Dolina (Atapuerca-Burgos)

Fig. 2. Equipo del MNCN-CSIC analizando fósiles del yacimiento del Sidrón (Piloña, Asturias)

Fig. 3. Cráneo de Sahelanthropus tchadensis vivió hace 6,8 a 7,2 m.a.

Fig. 4. Recreación errónea de nuestra evolución (izda.) y árbol evolutivo científico (dcha.) Dr. Ian Tattersall

Fig. 5. Museo de la Evolución Humana en Burgos

Fig. 1. El clima es un factor determinante a la hora de moldear los diferentes ecosistemas que existen a lo largo del planeta.

Fig. 2. A través de plataformas flotantes se recogen los sedimentos y los indicadores conservados en ellos acumulados durante miles de años en las cuencas de los lagos. Son nuestras máquinas del tiempo.

Fig. 1. Campo magnético terrestre e inversiones de polaridad. El registro de las inversiones de polaridad ha dado lugar a la Escala de Tiempo de Polaridad Geomagnética (ETPG), la cual puede usarse para saber la edad de una secuencia de rocas. Figura modificada de Langereis et al., (2010)

Fig. 2. Formación de las anomalías magnéticas del fondo oceánico (figura modificada de Butler, 1992). Las porciones negras de la corteza oceánica representan polaridades normales y las porciones blancas corresponden a polaridades inversas, todas adquiridas durante el enfriamiento de la corteza oceánica.

Fig. 3.Muestreo paleomagnético con perforadora eléctrica (a), de gasolina (b) y orientación de las muestras en el campo (c) y (d).

Fig. 1. Imágenes “tópicas” de profesores de química: en un anuncio publicitario (izda.) y en la popular película (The Nutty Professor) dirigida y protagonizada por Jerry Lewis en 1963. Se desea que los lectores de este capítulo aprecien estas imágenes con humor, pero alejadas de la realidad.

Fig. 2. El autor, explicando propiedades del “hielo seco” a jóvenes sorprendidos.
Referencia:

Fig. 1. Teoría de Orbitales Híbridos. No podéis imaginar la alegría que sentí cuando tuve que explicar esta teoría por primera vez y conseguí que mis alumnos la comprendieran. Y no solo eso, también conseguí, a través de esta explicación, comprenderla yo plenamente, cosa que no había conseguido hasta entonces.

Fig. 1. Químico malo visto por algunos.

Fig. 2. Mi profesora de Química.

Fig. 3. Ácido ascórbico, presente en el zumo de naranja.

Fig. 4. Bebé con metahemoglobinemia [1].

Fig. 5. Contaminación del río Tullahan entre Caloocan y Valenzuela (Filipinas) [3].

Fig. 6. (a) y (b) Degradación de la rodamina G con luz solar; (c) Espectrofotómetro UV-vis.


Fig. 1. Células cancerígenas (PANC-1) y fibroblastos humanos (hNDF) con una tinción DAPI (azúl: núcleo, rojo: citoesqueleto), visto con un microscopio.

Fig. 1. (+)-mentol

Fig. 2. Estructuras del halimedatrial (arriba) y del eritrolido (abajo).

Fig. 3. Verongiamida (también denominada dienona por su estructura molecular). Es un producto de alto valor añadido por su actividad biológica. Es presumible que en el futuro se cotizará en el mercado del sector biomédico y ayude a salvar vidas o a mejorar la calidad de vida de animales y hombres. Es un producto para la moderna “economía azul”.

Fig. 4. Espectro de 1H-RMN del metilimidazol (protones aromáticos) obtenido en la Universidad de Las Palmas de Gran Canaria.

Fig. 1. Los cuatro elementos griegos y sus símbolos. Aristóteles añadió la quinta esencia.


Fig. 2 (izquierda). Facsímile del libro “El arte de los metales”. Fig. 3 (derecha) Reproducción actual del experimento de Alonso.

Fig. 4. Planta petroquímica. Modelo de industria química pesada.

Fig. 5. Un viejo horno alto que transforma el mineral de hierro en hierro. Es uno de los más antiguos reactores industriales de régimen continuo.

Fig. 1. La Tecnología de Alimentos engloba todos los procesos que sufren las materias primas hasta convertirse en alimentos, desde los menos procesados como la fruta, o la carne fresca hasta los más procesados como las conservas, los precocinados o los fermentados.

Fig. 2. Imagen elaborada para la portada de mi Tesis Doctoral (Universidad Autónoma de Madrid, febrero 2009). Desde la estructura molecular del ADN del virus a la infección del cerdo.

Fig.1. Glaciares. A) Glaciar Breidamerkurjökull, Islandia. B) Morfologías lobulares localizadas en la mitad norte del monte central del cráter Gale, Marte.

Fig.2. Campos de dunas. A) Campo de dunas en Tatón, Argentina. B) Campo de dunas en el interior del cráter Trouvelot, Marte.

Fig. 1. Impresión artística del satélite GAIA de la Agencia Espacial Europea. Créditos: © ESA–D. Ducros, 2013, fuente ESA, web ESA.


Fig. 1. A la izquierda, el radiotelescopio de 30 metros del Instituto de Radioastronomía Milimétrica (IRAM), situado en el Pico Veleta, en Sierra Nevada. En el rango del espectro en que observa, éste es, sin temor a exagerar, el mejor telescopio del mundo, ¡y está aquí al lado! La fotografía es de Aniceto Porcel. A la derecha aparezco junto a dos colegas (Miguel Ángel Requena Torres y Nami Sakai) en la sala de control del telescopio. ¡Grandes momentos he pasado ahí dentro!

Fig. 1. El equilibrio de género se logró en una reunión reciente en Padua, Italia, donde los participantes y los oradores, todos astrónomos profesionales o estudiantes, fueron mitad mujeres y mitad hombres (¡dentro de las fluctuaciones estadísticas esperadas!).


Fig. 1. Carl Sagan y la portada de su libro “Cosmos” (1980). Este gran divulgador, con su estilo y la potencia de su mensaje, cambió a muchas personas la visión del universo y del propio papel y presencia de la raza humana dentro de él. También inspiró –como fue en mi caso- a una generación de astrónomos que nunca le estaremos lo suficientemente agradecidos. (Crédito: Sakman Hameed, Express Tribune Blogs).


Fig. 1. El detector de Super-Kamiokande en Japón cuando estaba siendo rellenado con los 50 millones de litros de agua, mientras científicos en una balsa comprueban las cámaras de fotos con forma de bombilla de las paredes. Imagen del observatorio de Kamioka [2].

Fig. 2. El sol por la noche visto con neutrinos. Crédito del observatorio de Kamioka [2].

Fig. 1. a) Foto de un cráter y varios cañones en Marte tomada por la sonda Mars Express. b) Plutón visto por la sonda New Horizons. c) Foto de la superficie de la luna Titán tomada por la sonda Huygens. d) Foto del hemisferio norte de Saturno y sus anillos tomada por la sonda Cassini. e) Foto de Cassini de los geiseres de agua de la luna Encelado.

Fig. 2. a) Imagen de la aurora de Júpiter. b) Foto del cometa Siding Spring (C/2013 A1) a su paso por Marte. Ambas imágenes fueron tomadas por el telescopio espacial Hubble.

Fig. 3. Representación de la tormenta solar gigante que llegó a Marte en Septiembre de 2017. Las líneas blancas representan el campo magnético interplanetario y las partículas de color naranja-rojizo el viento solar. El arco blanquecino alrededor de Marte representa el “choque de arco” que es producido por el impacto del viento solar con la alta atmósfera. El cuadrado inferior contiene observaciones de Mars Express de este evento, donde se aprecia un incremento de más de dos órdenes de magnitud en las partículas registradas por la nave.



Fig. 1: La mecánica cuántica puede parecer muy extraña a veces, pero también puede resultar muy divertida.

Fig. 2: Las partículas elementales son las piezas de Lego del universo… y también el pegamento que las mantiene unidas.

Fig. 3: El Modelo Estándar de la física de partículas.

Fig. 4: El bosón de Higgs, salvador del Modelo Estándar.

Fig. 5: Colisión de partículas en el LHC en la que se ha producido un bosón de Higgs.

Fig. 1. Grabado Flammarion (1888) mostrando un viajero que alcanza los confines de una Tierra plana, junto a una imagen de la Tierra tomada por el Apolo 17 en 1972. (Créditos: NASA).

Fig. 2. Imagen óptica del sistema lente “Cruz de Einstein”. El campo gravitatorio de una galaxia cercana (galaxia lente en rojo) produce cuatro imágenes de un mismo núcleo galáctico distante (imágenes A-D formando una cruz).

El resto de magnitudes se denominan derivadas y pueden expresarse en función de las siete anteriores. Esto hace imprescindible definir de forma rigurosa cada una de las unidades fundamentales. Veamos cuáles son las definiciones de algunas de ellas.
¿Sabías que la comida más cara del mundo, la trufa blanca, es un hongo? ¡Eso es! Con sabor muy agradable, la especie Tubermagnatum es un hongo que crece en suelo húmedo, en una región específica de Italia. Muchas peculiaridades hacen de éste el alimento más caro del mundo, pudiendo costar entre 2.500,00 y 4.000,00 euros el kilo.
¿Qué son los hongos?
El reino Fungi incluye levaduras, mohos y setas. Las levaduras son hongos unicelulares y microscópicos. El ejemplo más popular es Saccharomycescerevisiae, que participa en la producción de panes, pizzas, vinos y cervezas.
Por otro lado, el mayor ser vivo del planeta es un hongo multicelular de la especie Armillariasolidipes, que se extiende por un área de 9,6 km2, (¡más que 1200 Camp Nou juntos!).
Los mohos son multicelulares y forman estructuras aterciopeladas o con texturas de algodón. Las setas parecen pequeños paraguas, como los de Super Mario Bros. Algunas setas son comestibles, como el champiñón y el shitake; otras son altamente venenosas, como la Amanita phalloides, famosa por haber sido responsable de la muerte del papa Clemente VII. Es muy difícil diferenciar entre comestibles y venenosas, y corresponde a los micólogos esta tarea.
Otra forma fúngica se encuentra cuando los hongos desarrollan asociaciones de tipo mutualista con cianobacterias y algas, formando los líquenes.
Pero ¿qué tienen en común estos seres tan distintos?
La célula: su unidad microscópica estructural y funcional. Las células de los hongos son muy parecidas a las nuestras: ambas son eucarióticas y poseen mecanismos celulares similares. Sin embargo, existe una estructura externa a la célula fúngica que la diferencia de la célula animal y confiere al grupo la mayoría de sus características exclusivas: la pared celular.
Debido a la rigidez de la pared, los hongos no son capaces de realizar fagocitosis. Ellos liberan enzimas digestivas en el medio, que digieren el sustrato fuera de la célula, rompiendo las moléculas grandes en moléculas más pequeñas que se absorben. Los hongos son capaces de producir enzimas que digieren prácticamente todo, incluyendo tejidos, cuero, plumas, pelo, celulosa, madera, goma y varios productos derivados del petróleo.
Hongos y su papel ecológico 😀
Por su enorme versatilidad enzimática, los hongos son reconocidos como los agentes de degradación más importantes del planeta. Gracias a ellos, se reciclan los nutrientes contenidos en la materia orgánica, como restos de animales y vegetales.
Putrefacción y producción de micotoxinas 😖
Esta misma versatilidad enzimática puede generarnos pérdidas. Hay varios procesos para proteger nuestros alimentos de la putrefacción causada por hongos, como el secado, el salado, la congelación, el calentamiento, la irradiación y el uso de los aditivos químicos. Además de dañar los alimentos, algunas especies de hongos producen sustancias que son tóxicas para nuestro consumo, conocidas como micotoxinas. Los procesos arriba citados no las eliminan del medio. La micotoxina más notable es la aflatoxina, un compuesto altamente carcinogénico. Los micólogos se esfuerzan por mejorar los métodos de control e identificación de los hongos en alimentos y otros productos.
Micosis: infecciones en humanos y otros animales 😖
Otro desafío al que se enfrentan los micólogos es la prevención y la cura de micosis, que son infecciones causadas por los hongos. Cada hora 150 personas mueren por infección fúngica. La diversidad de antifúngicos disponibles es muy limitada y estos especialistas buscan obtener drogas más potentes. ¿Te acuerdas de la pared celular? Es una estructura esencial para el hongo que los animales no tienen. Por eso, esta estructura es muy estudiada por micólogos como diana para antifúngicos.
Infección en plantas y perjuicio económico 😖
Las plantas también son dianas de infecciones fúngicas, causando serias pérdidas económicas. Los hongos causantes de infecciones en las plantas se llaman fitopatógenos. Todavía queda mucho por descubrir sobre la biología básica y los ciclos de vida de estos hongos, por lo que el control de fitopatógenos exige una gran dedicación para los micólogos.
El control biológico por hongos 😀
Todos los tipos de plantas pueden ser infectados por hongos, incluyendo especies de malas hierbas, que causan serios problemas a los emprendimientos relacionados con tierras y áreas naturales. Los micólogos tuvieron la gran idea de usar hongos causantes de infección específicamente en las malas hierbas como agentes de control biológico.
No todos los hongos asociados a las plantas son perjudiciales para ellas. Algunos hongos en el suelo forman una red que permite a las plantas comunicarse entre sí y distribuir nutrientes. Los micelios de los hongos interactúan con las raíces de diferentes plantas y esto les permite compartir información sobre la presencia de insectos herbívoros, malas hierbas y hongos patógenos. Es como si una planta "hablara" con la otra. De esta manera, las plantas conectadas a esta red se protegen unas a otras. Esta interacción hongo-planta es conocida como micorriza y ocurre en cerca del 90% de las plantas terrestres.
Además, existen los hongos endófitos, que pueden estar presentes en las hojas y en los tallos de plantas sanas, protegiendo la planta de hongos patógenos y animales herbívoros. Entender cómo y qué hongo protege la planta y que otros factores que influyen esta asociación exige gran esfuerzo por parte de micólogos y genera buenos resultados de control biológico de plantaciones al mismo tiempo que disminuye el uso de agrotóxicos.
Hongos en la industria😀
El metabolismo de los hongos (primario o secundario, natural o inducido en laboratorio) tiene gran repercusión en la industria (alimentaria, farmacéutica y de otros productos). Los hongos son productores de antibióticos (como penicilina), de insecticidas, de medicamentos inmunosupresores usados después del trasplante de órganos (ciclosporina), reducen el colesterol (estatina) y son prometedores en el tratamiento del cáncer (taxol).
En la industria alimenticia, los hongos son los responsables de la existencia de los panes, vinos, cervezas, licores, chocolates, vinagres, ácido cítrico, tempeh, salsa de soja, dan los sabores específicos a los quesos Roquefort, Camembert, Brie y Gorgonzola. Además los propios hongos son consumidos, como algunas setas.
Asimismo, estos organismos son utilizados como pequeñas "fábricas" para la producción de vacunas, vitaminas, anticuerpos, diversas enzimas, ácidos (tales como el láctico y el oxálico) y otros compuestos biológicamente activos.
Organismos modelo😀
Algunos hongos se utilizan para estudiar procesos biológicos fundamentales de células eucariotas, porque poseen mecanismos genéticos comunes a otros organismos relacionados. La ventaja sobre otros sistemas como plantas y células animales es que el cultivo de hongos es fácil, simple, barato y rápido.
A modo de conclusión
Los hongos presentan complejos sistemas biológicos y bioquímicos que producen efectos positivos o negativos en la sociedad. Los micólogos de todo el mundo quieren entender estos seres para encontrar maneras de minimizar sus efectos negativos y maximizar sus puntos positivos.
"El mundo no descrito de los hongos puede ser visualizado como un recurso potencial masivo que espera ser comprendido" (Hawksworth). A pesar de esta enorme diversidad de habilidades que los hongos tienen y su papel en la salud, en la industria y en la ecología, muchas cosas sobre estos seres siguen siendo un misterio. Ser micólogo es aventurarse en un universo infinito de posibilidades.
¿Te atreves a participar en este desafío?
Notas:
Sarah C. Watkinson, Nicholas Money and Lynne Boddy, 2016. The Fungi(Third Edition).
Vanessa S. Dutra de Carvalho
Estudiante de Doctorado Microbiología y Genética Molecular
Universidad de Salamanca
Instituto de Biología Funcional y Genómica, CSIC
Ser microbiólogo no es algo que tengas claro desde la más tierna infancia. De hecho, cuando en los primeros años escolares te someten a la típica pregunta de: "y tú, ¿qué quieres ser de mayor?", a parte de las populares respuestas de princesas y astronautas, es raro encontrar una réplica más allá del "científico", siendo este caso muy extraordinario.

Fig. 1. río Tinto (Huelva)
Yo tenía clarísimo que la Naturaleza me interesaba y mucho, no solo por las asiduas visitas dominicales al zoo, la colección de cromos o mi afición por los documentales de Costeau, sino porque sentía que era una fuente inagotable de paisajes y especies distintas que convivían en más o menos armonía, de forma ordenada y a la vez enigmática. Pero había algo más, algo que no veía y que sin lugar a dudas, hacía que todo tuviera sentido, incluso en las condiciones más extremas. ¿Cómo podía haber vida a más de 100 ºC, en chimeneas hidrotermales y grietas volcánicas? ¿Y en el mar Muerto? Ya su propio nombre indica no ser demasiado hospitalario.
¿Qué es la microbiología?
Como puede adivinar el lector, esta ciencia se centra en el estudio de los microorganismos. Dentro de este colectivo de tamaño microscópico (de ahí su nombre), encontramos bacterias, virus y hongos, al igual que otros menos conocidos como arqueas, algas, protozoos, priones y viroides (Fig. 2). Los microbiólogos estudian la identificación y clasificación de microorganismos, tarea realmente ardua debido a la enorme diversidad de los mismos, incluyendo cerca de un trillón de especies bacterianas y 1031 virus [1]. En concreto, investigan su fisiología, morfología y genética, así como las interacciones con otros microorganismos, con su entorno y con anfitriones tales como el ser humano. De hecho, a nivel clínico, los microbiólogos son la llave entre el laboratorio y el paciente, desarrollando un papel fundamental en el diagnóstico y asesoramiento del tratamiento. En este trabajo, los retos que trae consigo la aparición de nuevas cepas patógenas, el resurgimiento de algunas antiguas y su expansión a través de poblaciones con una inmunidad más comprometida, posiciona a los microbiólogos como piezas claves en el contexto sanitario.

Fig. 2. La microbiología estudia diversos organismos de tamaño microscópico y multitud de formas.
Asimismo, crisis recientes como las del Ébola y la gripe aviar H5N1, dos tipos de virus con enorme virulencia y gran capacidad contagiosa, han podido ser gestionadas exitosamente gracias al desarrollo de la ciencia microbiológica.
Pero no todos los microorganismos suponen una amenaza en la vida diaria del ciudadano de a pie. Esto podemos comprobarlo en actividades tan cotidianas como el empleo de antisépticos en la higiene dental o comerse un yogur, producto de la fermentación combinada de Streptococcus thermophilus y Lactobacillus bulgaricus que lleva 4 milenios implementándose. Igualmente, si usted quiere fabricar cerveza artesanal en casa, convendría que conociese a las polifacéticas levaduras del género Saccharomyces. La cantidad de cereal, fuente de carbono y energía para las levaduras y sustrato de la fermentación de la cerveza, la cepa de levadura empleada así como el pH y la temperatura del proceso fermentativo determinarán que su producto final sea un elixir de placer o alcohol de quemar.
Microorganismos everywhere
No solo encontramos microorganismos en ambientes extremos, sino que realmente están en todas partes. Los microorganismos habitan todos los sitios del planeta y más allá. El mencionado ecosistema del río Tinto es un laboratorio vivo para la NASA debido a sus similitudes con el planeta Marte, arrojando importantes hallazgos acerca de la posible vida extraterrestre. Hasta hoy, han sido recuperados microorganismos con vida desde la estratosfera hasta en perforaciones de 4 km de profundidad, en nichos incrustados en fracturas rocosas y suspendidoas en el aire, ampliando los límites de nuestro concepto de biosfera. "El papel de lo infinitamente pequeño es infinitamente grande", dijo Louis Pasteur. Y tanto que lo es. Generalmente los encontramos viviendo en comunidades llamadas biofilms, complejos altamente especializados y compartimentalizados, funcionando como ciudades microbianas de una o varias especies. Estos biofilms son los que nutren los tapetes microbianos antárticos, los que obstruyen y corroen cañerías y los que se emplean en técnicas de biorremediación de ambientes contaminados. Además, las poblaciones en los biofilms pueden comunicarse mediante quorum sensing, un lenguaje químico que informa acerca de cuándo volverse patógenos, cuándo intercambiar información genética o cómo mantener el volumen de otras poblaciones vecinas a raya, entre otros. Por ejemplo, un desajuste en la microbiota oral fomenta la proliferación de biofilms de determinados estreptococos responsables de caries y sarro dental. De hecho, estos bichitos que requieren de microscopio para ser visualizados, habitan nuestra piel, nuestro sistema digestivo y genital, de forma que albergamos 10 células bacterianas por cada célula humana [3]. Visto así, ¡somos fundamentalmente colonias de microbios!
Por qué estudiar microorganismos
Quizás la razón fundamental es porque son imprescindibles para la vida. En nuestro caso, el microbioma humano (Fig. 3), que comprende además de arqueas, hongos y virus, entre 500 y 1000 especies bacterianas diferentes [2], es quizás tan abundante y diverso porque no solo nos ayudan a metabolizar alimentos, sino que llevan a cabo la síntesis de micronutrientes y vitaminas tan importantes como la B12 y la K. Gracias al conocimiento generado a raíz de su estudio se están realizando transplantes de microbiota intestinal con éxito, corrigiendo disbiosis microbianas tras el uso prolongado de antibióticos o como terapia eficaz para la enfermedad de Crohn.

Fig. 3. Microbiota normal humana [3].
Hemos comentado la existencia de varios microorganismos patógenos, causantes de enfermedades devasta-doras tales como el SIDA, la polio, la neumonía o la tuberculosis, para cuyo control, erradicación y prevención es funda-mental el conocimiento de su metabolismo y genética. Pese a la mala fama que tienen y al origen de su nombre, no todos los virus son veneno. Gracias a su aislamiento y estudio molecular se han podido emplear como eficientes agentes terapéuticos en procesos infecciosos, han sido cruciales en el desarrollo de vacunas desde la época de Edward Jenner (1749-1823, pionero de la vacuna contra la viruela) y la esperanza en varios tratamientos de control y prevención del cáncer, conocidas como terapias génicas. También hay microorganismos que desarrollan un papel esencial en la economía, pues múltiples cepas microbianas son de uso extensivo en la industria agroalimentaria, energética y biotecnológica. No solo se emplean en la fermentación de vinos y vinagres, curación de quesos y otros derivados lácteos, también son la base de la "fabricación" de múltiples fármacos. Además, son clave en la generación de biofuels o tratamientos de aguas. ¿Sabía usted que hay bacterias que se alimentan de residuos nucleares, de arsénico o mercurio? ¿Y otras como Geobacter o Shewanella, capaces de generar electricidad sin necesidad de mediadores artificiales? Así, en un futuro no tan lejano, los microorganismos podrían jugar un papel muy relevante como fuentes alternativas de energías renovables con un mínimo impacto en el medio ambiente. No solo el microbio entero es aprovechado sino que también algunas de sus partes como las enzimas, son de gran interés industrial a todas las escalas, desde los fermentadores industriales hasta el supermercado. Lipasas bacterianas son la base de los detergentes, se emplean proteasas para ablandar la carne o las xilanasas, que son responsables del blanqueamiento del papel, entre otros. Además, los microorganismos funcionan como modelos fundamentales en investigación, no solo por su rápido y relativamente fácil crecimiento, sino porque ejercen de patrón para organismos más complejos, por ejemplo, las bacterias fotosintéticas para plantas. No les mentiré, el trabajo del microbiólogo es fascinante, pero también duro y extenuante, como el de todo científico. Pese a la aparente simplicidad inicial que puede presentar nuestro objeto de estudio y trabajo, es impresionante la complejidad de las redes regulatorias de microorganismos que permiten su adaptación al medio y aceleran su desarrollo evolutivo, desafiando, por otro lado, nuestra comprensión. Por ejemplo, es pasmoso cómo puedes tardar meses hasta dar con la receta perfecta para hacer crecer en el laboratorio a una bacteria con una estructura celular simple y sin orgánulos ni compartimentos especializados, con un genoma mínimo y un ciclo vital básico.
Conclusiones finales
Mi fascinación por los microbios proviene no solo de su diversidad sino sobre todo de su plasticidad o capacidad para adaptarse a un ambiente en continuo cambio. Entre otras estrategias, son capaces de adquirir nuevos genes del microbio vecino, volverse virulentos o colonizar nuevos hábitats rápidamente si las circunstancias lo propician, o protegerse del enemigo secretando toxinas y camuflándose. Esta pluralidad morfológica, fisiológica y genética hace que los microorganismos sean una fuente de conocimiento y aplicación en áreas tan dispares, desde hacer pan hasta analizar muestras de agua de otros planetas o poder editar genomas a la carta. Así pues, es fácil imaginar que para el microbiólogo todos los días son maravillosamente diferentes. Además, desde un punto de vista laboral, siempre habrá un lugar para los microbiólogos ya que los microbios seguirán evolucionando rápidamente y siendo más listos. Nuevos mecanismos de resistencia emergerán, exigiéndonos desarrollar estrategias alternativas a las actuales para poder combatirlos. De igual manera, nuevos microorganismos se descubren diariamente y con ellos nuevas enzimas con un potencial interés clínico e industrial que explotar. Además, las tendencias de diagnóstico molecular que se están implementando en múltiples áreas experimentales, incluyendo la industria y la medicina, hacen del microbiólogo un activo solícito en este futuro próximo. Tal y como dijo Pasteur, "son los microbios los que tendrán la última palabra". Nuestro reto es precisamente comprenderla.
Referencias:
[1] Editorial. 2011. Microbiology by numbers. Nature Reviews Microbiology 9, 628.
[2] Sommer, F; Bäckhed, F. 2013. The gut microbiota:masters of host development and physiology. Nature Reviews Microbiology 11 (4): 227–38.
[3] Willey, Sherwood, y Woolverton. 2014. Prescott´s Microbiology, 9ª ed. MacGraw-Hill.
Alba Blesa Esteban
Doctor en Microbiología y Biología Molecular.
Profesor contratado doctor de la Universidad Francisco de Vitoria, Madrid
Si en este preciso instante no quieres ser microbiólogo será porque aún no conoces el apasionante mundo de las bacterias.
Las bacterias en nuestro día a día…
Para empezar, en tu cuerpo hay aproximadamente 40 billones de bacterias y alrededor de 30 billones de células humanas. Si, como lo oyes. Así que podríamos decir que somos mitad personas, mitad bacterias. Estas bacterias se encuentran principalmente en el colon, placa dental, saliva, intestino delgado, piel, estómago… y al conjunto de todas ellas lo llamamos MICROBIOTA. ¿Y se puede saber qué es lo que hacen todas estas bacterias habitando tu cuerpo? Pues comunicarse con tu cerebro. Te explico. El sistema nervioso del intestino y el sistema nervioso central se comunican de manera bidireccional y la microbiota intestinal juega un papel importante en dicha comunicación. De esta manera, el autismo, la enfermedad de Parkinson, la ansiedad, la depresión, el dolor crónico, la fibromialgia y la obesidad entre otros son, en parte, el resultado de una microbiota intestinal que interacciona de forma anómala con el eje cerebro-intestino. Por ejemplo, se ha visto que al modificar la microbiota en los ratones, también se modifica su comportamiento. Es decir, las bacterias hablan con nuestro cerebro. Así que es importante cuidarlas. Con todo esto no pretendo asustarte, si no hacerte ver la importancia que estos seres microscópicos tienen en tu vida.
Las bacterias en la historia de la humanidad…
Por otro lado, a lo largo de la historia de la humanidad, ha habido grandes epidemias como la tuberculosis, la peste, el cólera y la lepra; todas ellas causadas por bacterias. A día de hoy, estas enfermedades están todavía presentes y la OMS (Organización Mundial de la Salud) sigue reportando casos todos los años.
En concreto, la peste es una de las zoonosis (enfermedad que se puede transmitir entre humanos y animales) más antiguas que se conoce y ha llegado a considerarse como una de las plagas más grandes y letales de la historia. La bacteria que la causa es Yersinia pestis, la pulga es el vector que la transmite mediante su picadura y la rata es el reservorio. La primera plaga conocida causada por esta bacteria es la plaga de Justiniano que tuvo lugar en el siglo VI en el imperio bizantino. Llegó a ocasionar unas 10.000 muertes al día con un total aproximado de 30.000.000 de muertes. Es más, se considera que acabó con la vida de la mitad de la población en esas regiones. La segunda fue la peste negra en el siglo XIX que produjo 75 millones de muertes. La última fue la tercera pandemia, en los siglos XIX-XX, que causó 12 millones de muertes.
Pero quiero que te quedes con un solo dato de todo esto. En cada una de estas plagas, fue una única bacteria o cepa la que salió fuera de control siendo capaz de propagarse y causar todas estas muertes.
Los antibióticos…
Afortunadamente, Alexander Fleming descubrió la penicilina en 1928 que fue el primer antibiótico de uso clínico. Un antibiótico, es una sustancia natural producida por un organismo (bacterias, hongos) o un derivado sintético que, a altas concentraciones, mata o impide el crecimiento de microorganismos sensibles. ¿Y cómo descubrió Fleming la penicilina? Pues resulta que se dejó olvidada en su mesa de trabajo una placa de petri, en donde estaba cultivando sus bacterias. Al cabo de los días, observó que había crecido un hongo y que alrededor de dicho hongo sus bacterias no crecían. De ahí, dedujo que el hongo debía de producir alguna sustancia que impedía el crecimiento de las bacterias. Y es que muchos de los grandes descubrimientos se han realizado por casualidad. En concreto, el descubrimiento de los antibióticos es considerado como uno de los mayores descubrimientos biomédicos de la historia ya que enfermedades que eran hasta entonces mortales pudieron empezar a curarse. De esta forma, los antibióticos hicieron que aumentase enormemente la esperanza de vida ligado a una disminución de la mortalidad infantil y a un aumento de la población mundial a partir de que comenzaran a comercializarse.
La resistencia a los antibióticos…
Pero las bacterias tienen una gran capacidad de adaptación debida principalmente a tres razones. Forman grandes poblaciones, tienen capacidad para mutar (al igual que cualquier célula, cometen errores) y pueden pasarse material genético entre bacterias vecinas. Todo esto hace que las bacterias puedan desarrollar o adquirir resistencia a los antibióticos. Nosotros, cuando tomamos antibióticos lo que hacemos es matar a las bacterias sensibles y seleccionar a las bacterias resistentes que al encontrase solas, tienen vía libre para multiplicarse. Por eso, si hacemos un mal uso de los antibióticos favorecemos la selección y propagación de estas bacterias resistentes. Y eso, lamentablemente, es lo que hemos estado haciendo durante muchos años. De esta manera, la resistencia a antibióticos se ha convertido en uno de los mayores desafíos biomédicos de la actualidad. Si no ponemos remedio, las infecciones causadas por estas ‘superbacterias’ resistentes a antibióticos serán la primera causa de muerte para el año 2050.
Qué hace un microbiólogo y qué puede llegar a descubrir…
Para llegar a ser microbióloga yo estudié veterinaria. Si, si, has oído bien. De todas formas, se puede llegar a ser microbiólogo por muchas otras vías y te diré por qué. Hace algunos años que apareció el concepto de "One Health" ("Una salud"). Este concepto pone de manifiesto que la salud humana y la animal son dependientes entre si y a su vez están ligadas a la salud de los ecosistemas. Esto se ha implementado como una aproximación colaborativa global para entender los riesgos de la salud humana, animal y de los ecosistemas como un todo. Los riesgos han aumentado con la globalización, cambio climático y cambios en el comportamiento humano y por tanto las oportunidades de colonizar nuevos territorios por parte de los microorganismos patógenos (bacterias, virus, hongos, protozoos) son mayores. Por tanto, veterinarios, médicos, biólogos, ecólogos, etc. deben trabajar juntos para poder abordar el problema de la mejor manera posible. Además, el 60% de las enfermedades infecciosas humanas existentes son zoonosis que, como ya dijimos, se pueden transmitir entre humanos y animales y viceversa. Además, al menos el 75% de las enfermedades infecciosas emergentes en humanos (incluyendo el ébola, gripe y VIH) tienen un origen animal.
Yo, en concreto, me dedico a crear un nuevo sistema para matar a las bacterias, pero sólo a las que yo quiero. A las malas. ¿Y cómo lo hago? Pues resulta que las bacterias tienen un sistema inmune que utilizan para defenderse de los virus que las atacan, los bacteriófagos (los come bacterias). Este sistema se llama CRISPR-Cas y está muy de moda porque se han encontrado muchísimas aplicaciones derivadas de su descubrimiento, entre ellas, la que estamos desarrollando en mi laboratorio. El caso, es que las bacterias son capaces de coger secuencias muy pequeñas del ADN del virus que las está infectando y guardárselas insertándolas en su propio genoma. Si las bacterias sobreviven a la infección pasarán esta información a sus bacterias hijas. De esta manera, la próxima vez que estas bacterias son atacadas por un virus parecido, sintetizan esos pedacitos de ADN del virus que junto con una proteína van en búsqueda del virus. Si encuentran esa misma secuencia en el ADN del virus, la cortan y el virus no consigue infectarlas ganando las bacterias la batalla. Pues en mi laboratorio, lo que hacemos es programar a las bacterias para que sinteticen secuencias de su propio genoma de manera que acaben cortando su propio ADN y al no poder repararlo, mueran. Lo importante aquí es lo siguiente. Por una parte, eres capaz de elegir a qué tipo de bacterias te quieres dirigir ya que eres tú el que eliges la secuencia de ADN que quieres cortar. Por tanto, tan sólo matas a las bacterias que te interesan sin causar daño al resto de tu microbiota, que, como ya comentamos al principio, es muy importante. Por otro lado, si apareciese alguna bacteria resistente, al no matar al resto de bacterias de tu microbiota, estas segundas pueden desplazar rápidamente a dicha bacteria resistente.

Para que os hagáis una idea, en mi día a día siembro bacterias en una placa de Petri y al principio no veo nada. Son diminutas, pero están ahí. Por la noche, me voy a la cama y mientras duermo profundamente ellas se multiplican, se transmiten información de madres a hijas y entre bacterias vecinas, mutan, evolucionan. A la mañana siguiente me despierto y siento que soy la misma, pero las bacterias de mi cuerpo también se han dividido, han evolucionado y yo con ellas. Quizás no sea exactamente la misma persona que ayer. Voy al laboratorio y observo mi placa. ¡Allí están! Donde ayer había bacterias invisibles a simple vista han aparecido colonias o puntitos formados por millones de bacterias hijas de aquellas bacterias aisladas que cayeron en mi placa.
Podría continuar horas y horas hablando de en qué consiste ser microbiólogo pero espero que llegados a este punto, seas tú mismo el que lo descubras.
Belén Gutiérrez Soriano
Doctora en Microbiología y Ciencias Veterinarias
Instituto Pasteur, Laboratorio de Biología Sintética.
"Yo quiero ser modelizador de moléculas". Así me hubiera gustado contar que se me ocurrió la idea de qué hacer con mi vida profesional cuando estaba en el instituto. Así, con un deseo claro y una determinación firme; con una decisión sin lugar a la duda que me proporcionara la seguridad de haber respondido satisfactoriamente a esa pregunta que tanto nos repiten en la infancia (y que tanto nos repetimos): ¿Y tú qué quieres ser de mayor?
Como te puedes imaginar esta vocación no aparece de un día para otro, no hay una mañana en la que te levantes y digas: "¡Ya lo tengo!, químico teórico" (porque eso es lo que soy de formación). No, la verdad es que es un proceso que se forja poco a poco; de hecho, allá cuando iba a la secundaria apenas tenía idea de lo que era la química teórica ya que se la mencionaban de una forma muy aislada en el último curso, en COU. Menos si cabe se hablaba de su aplicación a los computadores, que son los que verdaderamente nos permiten modelizar… pero déjame que vaya paso a paso.
¿En qué consiste modelizar moléculas?
Como sabes el mundo que nos rodea está compuesto de átomos, unidades muy pequeñas de materia que en la antigüedad se creían como indivisibles. Hoy en día, sabemos que los átomos están constituidos por un núcleo cargado positivamente y de una especie de nube rodeándolo formada por unas partículas cargadas negativamente, los electrones. También sabemos que los núcleos se pueden romper liberando gran cantidad de energía (en un proceso llamado fisión), y que sus partículas constituyentes son los neutrones y protones, que a su vez están constituidas por otras más pequeñas llamadas quarks (más sobre esto en el Capítulo de José I. Crespo-Anadón de este mismo libro). Pues bien, los químicos (y físicos) teóricos que nos dedicamos a modelizar moléculas nos quedamos en un nivel atómico, es decir, estudiamos con métodos matemáticos (modelizamos) cómo los electrones interactúan con los núcleos entre sí, tanto con el de su mismo átomo como con el de los vecinos. Cuando dos o más átomos comparten electrones decimos que se ha formado un enlace, y el predecir cuándo esto ocurre y con qué fuerza lo hace es uno de nuestros objetivos.
¿Es esto importante? Seguro, mira al mundo que te rodea. Yo ahora mismo estoy sentado en una silla de plástico generada por compactación de polímeros que hacen una estructura sólida capaz de resistir mi peso. Al lado tengo una taza de café, hecha de un material poroso capaz de aguantar altas temperaturas y recubierta por un esmalte que le protege de que el agua entre en su interior. Todos estos materiales que me rodean (¡incluso el aire que respiro!) está constituido por las mismas cosas: electrones y núcleos interaccionando entre sí. Sorprendente, ¿verdad? Pues espera: desde el punto de vista matemático los electrones y los núcleos sólo pueden interactuar de una misma forma, mediante la llamada interacción coulombiana. De seguro que ya te es familiar la Ley de Coulomb, aquella que establece que la fuerza con la que dos cargas interactúan entre sí es directamente proporcional a su carga dividida por la distancia que los separa al cuadrado. Es ésta misma fuerza la que se aplica aquí, la misma que encontrarás entre los átomos de una silla, una taza de café o de los gases de un planeta a millones de años luz de la Tierra.
Puedes estar pensando, "¡Vaya cosa! una simple ley para todo, tu trabajo sí que tiene que ser fácil". Y no te falta razón, salvo por el pequeño detalle de que los electrones (y los átomos en menor medida) son partículas cuánticas, es decir, nunca podemos saber de una forma exacta dónde "están" porque para medirlos y determinar su posición necesitamos usar haces de luz que a su vez alterarían su posición. Es como si pidieran localizar a ciegas a un gato en una habitación y para ello te dieran una aguja con la cual pincharlo. Una vez que lo "localizaras" pinchándole, de seguro que habría salido a todo correr por la habitación y su localización ya no sería ni mucho menos la inicial. Esto, que parece una cosa muy rara y mística, es algo intrínseco a la Naturaleza y forma parte de lo que se conoce como dualidad onda-corpúsculo de la materia, la cual es más notable cuanto más pequeños son los objetos. En consecuencia, si queremos predecir cómo los electrones se van a comportar en una determinada situación (en un enlace de una red cristalina, en una superficie de un metal o en un líquido a temperatura super-crítica) tenemos que abandonar la idea de certitud y forzar a nuestros modelos a trabajar con probabilidades. Es decir, tenemos que pasar de los modelos clásicos que usan una descripción Newtoniana a los modelos cuánticos donde esa incertidumbre sobre la localización está tenida en cuenta. Las ecuaciones resultantes no son nada fáciles de resolver, de hecho, el describir de una forma exacta el movimiento de dos electrones en una disociación de una molécula de H2 requiere el uso de centros de computación de alto rendimiento (o HPC, por sus siglas en inglés), donde cientos de procesadores trabajan en paralelo durante varias semanas. Al igual que el BigData análisis, la predicción del tiempo meteorológico o simulación de la formación del universo; la resolución de movimientos tan simples como el de dos electrones en dos núcleos, también representa un reto desafiante desde el punto de vista científico y tecnológico.
¿Y para qué sirve?
Actualmente, la modelización de moléculas en un ordenador es una herramienta estandarizada en casi todos los laboratorios de investigación alrededor del mundo. El porqué es simple: Las simulaciones nos ayuda a comprender cómo la Naturaleza realmente funciona ya que nos proporcionan una visión de los procesos químicos y físicos a nivel atómico, es decir, con una resolución mucho más elevada de la que podemos obtener en cualquier experimento de laboratorio. Esto se traduce, de una forma más pragmática, en ahorro de tiempo y de dinero. Para saber cómo, déjame que te ilustre un par de ejemplos:
-En el desarrollo de nuevos fármacos es imprescindible el estudio de lo que se llama interacción de medicamento-ligando [1]. La gran mayoría de las medicinas que tomamos actúan sobre determinadas proteínas, en su mayoría enzimas o co-factores, que regulan alguna función importante de nuestro cuerpo. Para proponer nuevos medicamentos, los científicos (farmacólogos, biólogos, químicos, etc.) tienen en mente una gran cantidad de principios activos (también conocidos por APIs, nuevamente por sus siglas en inglés) que son moléculas fáciles de sintetizar y con una potencial actividad química frente a la proteína objetivo, ya sea bien porque dificultan o bloquean su actividad encimática. Dependiendo de la naturaleza de la proteína y de sus características de reactividad, la preselección de AIPs pude variar entre unos pocos cientos a unos varios miles de moléculas. Antiguamente, para cada una de ellas se llevaban a cabo un test actividad in-vivo, es decir, se probaba su actividad en un caso real mediante un cultivo de células vivas. Hoy en día, gracias a la llegada modelización molecular este gasto de dinero y tiempo de pruebas se ha reducido drásticamente ya que, en vez de ir al laboratorio, los técnicos insertan el conjunto de AIPs en el ordenador y calculan su afinidad frente a la proteína mediante cálculos cuánticos. En vez de varios días de arduo trabajo de laboratorio, los resultados teóricos pueden estar en cuestión de horas. Obviamente su fiabilidad depende de la precisión de los modelos teóricos en los que éstos estén basados, algo que hoy es un campo muy activo de investigación. Además, una vez aislado el AIP más reactivo la siguiente fase en el desarrollo del nuevo fármaco es su síntesis en una forma sólida y estable para facilitar su administración a los pacientes (por ejemplo en forma de una pastilla). El inconveniente es, sin embargo, que los AIPs son por norma general especies orgánicas que cristalizan en diferentes formas llamadas alótropos. Cada alótropo tiene unas condiciones en la que es estable y fuera de ese rango puede que la red cristalina cambie a otra que, por ejemplo, haga que el fármaco no se disuelva en nuestro intestino. Es por ello que el calcular en qué condiciones ese tipo de cambios polimórficos se van a producir sea una prioridad para las empresas farmacéuticas. De hecho muchas de ellas siguen ampliando su dotación de expertos en modelización con el fin de mejorar los modelos y programas de simulación de cambio de estructuras [2].
-Desarrollo de celdas solares. No cabe duda de que los carburantes de origen fósil de los cuales dependemos hoy en día para nuestro transporte y generación de luz eléctrica, también contribuyen a la contaminación de la atmósfera y al llamado efecto invernadero que está aumentando la temperatura global de la Tierra.

Fig. 1. Ejemplo de paneles bio-solares en la Vrije University, Ámsterdam.
En la búsqueda de alternativas, los científicos han desarrollado los llamados paneles solares que son dispositivos que generan electricidad mediante la absorción de luz visible. Dentro de ellos, los paneles biosolares representan una opción incluso más amigable con el medio ambiente ya que en su interior contienen algas verdes naturales (Fig. 1). Las algas, al igual que las plantas comunes, contienen moléculas de clorofila que son las responsables de la absorción de la luz en la región del rojo (400-500nm, de ahí su color verde). Este rango de absorción se puede modificar indirectamente mediante la mutación de las proteínas que rodean a las clorofilas y que las mantienen fijas en posiciones del espacio concretas [3]. Es decir, usando técnicas de manipulación genética se puede cambiar los aminoácidos de la proteína responsables de las uniones con las clorofilas, haciendo que su absorción sea mucho mayor incluso en la presencia de luces mucho más tenues. Así, podemos pensar en una celda biosolar ideal en la que las algas maximizaran la generación de corriente eléctrica incluso en las horas del atardecer donde la luz solar que llega es menos intensa. La realidad, sin embargo, es un poco más compleja ya que lo difícil de esta idea es dar con la sustitución de aminoácidos (mutación) que produjera este efecto en las clorofilas. Hay que saber cuál de los cerca de 300 aminoácidos de la proteína hay que cambiar; y no sólo eso, sino también determinar por cuál de ellos hay que sustituirlo. Nuevamente, no es necesario emprender la ardua tarea de mutar en el laboratorio cada uno de los aminoácidos por cada uno de los posibles candidatos (cerca de unas 4000 pruebas), ya que la modelización computacional nos permite generar las diferentes especies mutadas de la proteína y calcular su efecto sobre la absorción de las clorofilas colindantes, todo ello en el ordenador y de forma virtual. Así los miles candidatos pueden ser cribados en unas pocas horas a unas pocas decenas, reduciendo gasto y tiempo de laboratorio.
Bibliografía:
[1] Protein-Ligand interactions, from Molecular Recognition to Drug Design. Edited by H.-J. Böhm and G. Schneider. Wiley-VCH 2003.
[2] La predicción de cambios alotrópicos es realmente un tema candente. De hecho, el Centro de Datos de la Universidad de Cambridge (UK) convoca cada año una competición en la que se entrega una molécula test y los participantes deben predecir en qué estructura cristalizaría a una determinadas condiciones de presión y temperatura.
[3] S. Choi, Biosensors and Bioelectronics 69 (2015) 8–25.
Pablo López Tarifa
Doctor en Química.
Investigador postdoctoral en la Vrije Universiteit, Amsterdam.
Seguro que si lees este artículo es porque te gustan las Ciencias y además sientes un gran interés por todos los avances que la Biología está experimentando en los últimos años. Actualmente la Biología es una de las fronteras en el saber del ser humano y el progresivo conocimiento de cómo funciona la vida nos está permitiendo, entre otras cosas, solucionar muchas enfermedades hasta hace poco incurables. Podemos decir que algo revolucionario está sucediendo en nuestra concepción biológica, y disciplinas como la genómica, es decir el estudio de los genes y sus aplicaciones, se ha comparado con diversos logros como la llegada del hombre a la luna, el desarrollo de las vacunas, la electricidad o internet. Es un reto apasionante y es posible que quieras participar en su desarrollo.
Pero la Biología es todavía más que esto. Es conocer cómo viven los distintos seres vivos que habitan en la Tierra y como se relacionan entre ellos; es aprender a proteger ese equilibrio tan perfecto, y a la vez tan delicado, que es la naturaleza. Tu curiosidad, e incluso tu amor por esta, puede ser otra de las razones por la que te atrae la Biología. Sientes que quieres proteger el medio ambiente en su conjunto y piensas en la Biología como la profesión para saber cómo hacerlo desde un punto de vista científico.
Independientemente de cuál sea tu interés por la Biología, permíteme también decirte que es muy posible que tengas dudas sobre la conveniencia de elegir esta profesión entre otras que puedas estar barajando, tal y como a mí me pasó. Mi interés al escribir este artículo es que mi experiencia pueda servirte de guía para ayudarte a tomar tu decisión y que elijas la Biología con la pasión que yo lo hice.
Puede que tus dudas a la hora de elegir Biología provengan de haber escuchado que si tal y cual carrera tienen mejor salida profesional que otras. Es normal. Todos los padres quieren lo mejor para sus hijos y eso implica, para la mayoría de ellos, un título universitario relacionado con un puesto de trabajo estable y con cierto reconocimiento social.

Fig. 1. Fauna Ibérica. El hombre y la Tierra. Félix Rodríguez de la Fuente. (Crédito: De Richard Bartz, Munich aka Makro Freak - Trabajo propio, CC BY-SA 2.5, )
Pero las personas debemos encontrar nuestro elemento, que es aquello que en un 50% se nos da bien y en el otro 50% nos gusta. Quien encuentra el suyo será una persona realizada profesionalmente, lo que contribuirá a que se sienta feliz y segura de sí misma en muchas otras facetas de la vida, pues dedicarse a lo que a uno le gusta es un factor esencial en la realización personal de todo ser humano.
En el momento de tomar tu decisión, y aunque sientas que te estás equivocando, piensa que nada es determinante y no hay "trabajo para toda la vida". Pero elijas lo que elijas recuerda siempre que todo cuesta esfuerzos y debes poner todo tu empeño. Apuesta por tu felicidad, comprométete con ello, vívelo con pasión y sorprende a todos, a tu familia y a la sociedad.
¿Por qué yo me hice biólogo?
En mi caso y desde pequeño me ha gustado mucho la naturaleza. Aunque nací en una ciudad grande, una de las actividades de ocio que más he practicado han sido las salidas al campo, primero con mis padres y después con mis amigos. Estar en contacto con la naturaleza me permitió disfrutarla, quererla y por supuesto respetarla. Lo seres vivos empezaron a fascinarme, y esta fascinación se vio incrementada gracias a la serie de televisión dirigida por Félix Rodríguez de la Fuente, famoso naturalista y divulgador ambientalista de los años setenta. Sus capítulos eran historias de la naturaleza llenas de fuerza, drama y poesía; y aunque desde el punto de vista actual puedan tener alguna crítica, he de reconocer la influencia que en mí tuvo este divulgador, lo mismo que en muchos chavales de mi generación.
Cuando llegó el momento de elegir carrera dudé entre Biología y Medicina. El conocimiento del cuerpo humano también me gustaba mucho, y la perspectiva de ayudar a mis semejantes era un potente aliciente. Además mis padres me animaban a escoger esta última carrera. Pero los animales y las plantas, y la naturaleza que había disfrutado desde mi niñez, pudieron más y al final me decanté por Biología, aunque con lógicas dudas.
Tras un primer curso estudiando asignaturas generales, en segundo descubrí la Bioquímica y esto supuso mi primer cambio de dirección. Me seguía gustando la naturaleza pero la Bioquímica de segundo, y después la Genética de tercero, me fascinaron. En ese momento quería conocer con todo detalle los mecanismos moleculares mediante los cuales funciona la vida. Y con ese interés terminé la carrera con la especialización de Bioquímica.

Fig. 2. Recreación artística del RNA. (Crédito: vossman wikipedia commons)
Tras mi licenciatura, y como muchos biólogos hemos hecho, dediqué algunos años a la investigación, en concreto a la Genética molecular, una de esas fronteras a las cuales hacía referencia al principio del artículo.
Sin embargo la vida siempre te reserva sorpresas y de nuevo cambié de dirección. Os recomiendo estar abiertos a nuevas ideas y proyectos, y atreverse a tomar decisiones que en muchos casos implican salir de la zona de confort, pero que os permitirán acometer gratificantes retos. En mi caso el reto fue que algunos de mis compañeros de facultad empezaban a trabajar en una disciplina, relativamente nueva en los años ochenta, que es la Bioinformática. La combinación de bioquímica y genética, junto con la popularización de los ordenadores personales que tuvo lugar en esa década, me permitió descubrir un nuevo mundo que quería explorar.
Pero mis compañeros y yo quisimos ir un paso más allá y tres de nosotros creamos una "start-up" a finales de los años ochenta, una pequeña empresa cuya finalidad era desarrollar sistemas informáticos capaces de facilitar el avance de la biología y de la medicina. Empezamos diseñando programas informáticos para vislumbrar, de una forma muy rudimentaria, la estructura espacial de las proteínas, y treinta años después, esa pequeña empresa, de la cual soy fundador y director, tiene sistemas informáticos instalados en cientos de hospitales de todo el mundo con finalidades tales como facilitar el trabajo de los médicos a la hora de seleccionar la sangre más compatible en una transfusión sanguínea, asegurar la calidad del trasplante de células madres a pacientes con algunos tipos de cáncer, o el trasplante de órganos, o la alimentación de bebes prematuros con productos derivados de la leche materna. Siento orgullo al deciros que estas herramientas informáticas han ayudado a salvar vidas y he cumplido con aquel aliciente que tuve de joven cuando dudaba entre Biología y Medicina. Finalmente mi vida profesional ha girado en torno a las Ciencias Biomédicas.
Para concluir…
Como habéis podido leer, mi curiosidad e interés por la naturaleza me llevó a la pasión por el funcionamiento molecular de la vida y de ahí a desarrollar herramientas informáticas que ayuden a otras personas. Y en todo momento puse empeño y esfuerzo para conseguir lo que me proponía.
Mi interés por el conocimiento no ha decrecido con los años y ahora me siento atraído por asuntos tan vanguardistas como el Big Data, o tratamiento informático de datos masivos, en la investigación biológica; o como la Física cuántica puede ayudarnos a profundizar todavía más en el conocimiento de la vida.
Si ya tenías interés por las Ciencias, espero que este artículo te haya ayudado a concretarlo en las Ciencias Biomédicas, y a decidirte a ser emprendedor cuando hayas adquirido la experiencia adecuada. Crear tu propia empresa no es solo asunto de economistas o informáticos. Muchos científicos biomédicos también decidieron ser emprendedores y su esfuerzo ha aportado importantes avances capaces de resolver problemas sanitarios y de facilitar la vida de los demás.
¿Por qué tú no eres el siguiente?
Pedro Pereda Gómez
Licenciado en Biología
Director de Hemasoft
Divulgar ciencia es útil. A todos, también (o más) a la comunidad investigadora. Porque despierta vocaciones científicas entre los más pequeños, cuando más firmemente se afianza este deseo [1]. Como en el fútbol, la ciencia también tiene que cuidar de su cantera. ¿Cuántas generaciones de biólogos Españoles deberán su vocación a las inspiradoras palabras de Félix Rodríguez de la Fuente? ¿Cuántos de esos lograrán descubrir, con el sudor y entusiasmo de una vocación firme, las causas/tratamiento/prevención para el Alzheimer, Parkinson, o tantas otras enfermedades devastadoras?

Crédito imagen: Cikus. Consejos para un/a joven que descubre que su vocación es entender el cerebro.
Pequeño o pequeña, si quieres ser neurocientífico (o neurocientífica, que todavía más falta hacen [2]), déjame decirte unas palabras.
Enhorabuena por elegir una profesión con futuro. Como dice un gran cerebro de este país, José María Delgado-García, "los neurocientíficos seremos los últimos profesionales en ir al paro por falta de trabajo" [3] (yo lo escuché hace ya algunos años en su clásico "Curso Nacional de Neurociencia", por entonces en su décima edición). Con esto, el profesor se refería al vasto terreno que todavía permanece inexplorado en cuanto a lo que conocemos sobre el cerebro. Aunque queda por ver si esta máxima será cierta en nuestro país, sigue siendo válido en el resto del mundo. La neurociencia cada vez interesa más a todos. Un indicador son los famosos megaproyectos de investigación "Human Brain Project" y "BRAIN", con presupuestos galácticos concedidos hace apenas dos años a ambos lados del atlántico.
Ser científico y estudiar el cerebro es una de las profesiones más exóticas que puedas imaginar. Cuando expliques tu trabajo a conocidos y amigos, verás sus pupilas ensanchar de asombro. Ser neurocientífico significa dedicarse a entender el órgano más complejo del universo. Significa tener el privilegio y oportunidad de añadir un granito de arena al vasto desierto (todavía prácticamente desconocido) de lo que sabemos sobre esta máquina de computación, y poder escribir una línea corta pero imborrable en la historia de la neurociencia. En definitiva, significa contribuir a descifrar una esquina de una de las miles de páginas del manual de instrucciones del cerebro, el órgano que nos hace ser lo que somos, lo que pensamos, sentimos, queremos y hacemos, a partir de chispas de electricidad que transcurren y saltan entre miles de millones de neuronas conectadas en centenares de formas distintas. Pero sin magia alguna.
Como científico, te lanzarás a una aventura sustentada en la curiosidad, el optimismo y el entusiasmo. En la convicción de que la exploración, por penosa y larga que sea, merece la pena. Y también en el inconformismo. Quien no discrepa no puede encontrar ideas mejores (más cercanas a la realidad). Como neurocientífico, estarás inmerso en una empresa colectiva que tendrá un impacto social tremendo a muchos niveles. Aun hay que darle tiempo, pero con seguridad será protagonista en la salud del futuro, porque el envejecimiento de la población conlleva más problemas en el cerebro (como las demencias o el Alzheimer), ya que las neuronas en su inmensa mayoría no se regeneran (como si hacen las células del hígado o la piel). La neurociencia también tendrá importantes aplicaciones tecnológicas con un impacto económico notable (para mí, las más sorprendentes ocurrirán en la alianza neurociencia - robótica: tarde o temprano tendremos en las casas máquinas "pensantes" con "cerebros" que simulen el nuestro y sean capaces de escucharnos, comprendernos y responder en consecuencia, como si fueran una "persona" más). Los entrecomillados sólo para estimular la reflexión sobre las tremendas implicaciones filosóficas que eso conlleva.
En realidad, ser neurocientífico significa más cosas en el día a día. Mes a mes y año a año, tendrás permanentemente el reto de aprender algo nuevo. Al principio, tendrás que leer y ponerte al día para convertirte en un experto en tu campo (hay miles de campos, también dentro de las neurociencias, pero tendrás que elegir uno). Cuando seas el que más sabe, sabrás qué es lo que queda por conocer. Plantearás tu hipótesis, tu creación intelectual, una versión del mundo originalmente tuya. Una especulación sobre el cerebro que todavía sólo existe en tu cabeza, como la mente mirándose a sí misma (o en palabras del profesor Ignacio Morgado "es por la mente que llegamos al cuerpo del que ella depende" [4]).
Entonces tendrás que poner a prueba tu hipótesis planteando un experimento que demuestre si es falsa o no. De algún modo, tendrás que ser tu peor enemigo para sacarle a tu idea todas las pegas que seas capaz de imaginar. Lo que viene después, un torbellino de datos, datos, datos, análisis, análisis, análisis, gráficos, un poster que defenderás en un congreso en Honolulu, un manuscrito que tras 40 revisiones intentarás publicar en la mejor revista científica, probablemente rechazarán, de nuevo a revisar y enviar a otra revista, y otra, para varios meses después recibir, por fin, la carta del editor: Hemos decidido aceptar su manuscrito para su publicación en la revista … A descorchar el champán, un sorbito, y a por el siguiente.
En esencia, esto significa que entre un día y el siguiente habrá un parecido tan grande como el que existe entre un huevo y una castaña. Un día observarás en el microscopio una muestra de cerebro donde las neuronas activadas durante un aprendizaje el día anterior se rellenaron con una proteína fluorescente que colorea el contorno arbóreo de una red neuronal que representa internamente esa memoria. Otra semana, dedicarás horas eternas aprendiendo un programa de ordenador que te haga las gráficas y estadísticas. Otra semana de viaje a tu primer congreso de la Sociedad Española de Neurociencia, o el Foro Europeo de Neurociencia, donde darás tu primera charla (mano temblorosa sujetando el puntero laser rodeando una gigantesca gráfica proyectada en la pantalla) ante una selecta audiencia de expertos con barba cana y ojos inquisidores. Otra semana escribirás tu tesis (y varias semanas más), o un manuscrito, o abrirás el champán tras publicarlos.
¿Te parece fascinante? Lo es, pero espera, esta no es toda la historia. Nadie dijo que fuera fácil. A veces, para bien o para mal, será duro.
La investigación no es como un cuento de hadas. Tendrás que trabajar duro y muchas veces los experimentos no saldrán como esperas. Aunque técnicamente el experimento sea impecable (nunca olvides la importancia de los controles positivos y negativos), esto es normal porque el cerebro no tiene por qué ser como imaginas. Por otro lado, la investigación es muy competitiva. En parte, por eso mismo la ciencia es un sistema robusto y así es cómo se filtran las verdades, sometiendo las pruebas e ideas a una crítica feroz. Otros científicos expertos en tu campo criticaran tu trabajo, y tendrás que esforzarte y hacer las cosas muy bien para convencerlos de que lo que haces permite concluir lo que piensas. También es cierto que los científicos tienen sus ambiciones y defectos, algunos te caerán bien y otros peor, como cualquier otra persona. Algunos te pondrán zancadillas, otros te ayudarán. Con todo, aprenderás a ser un pensador independiente y cómo abordar las preguntas científicas que te interesan.
Más cosas que nunca debes olvidar. Que no te confunda el éxito. Hay quien falsifica datos, y según varias encuestas un porcentaje demasiado alto de investigadores saben de colegas que han hecho este tipo de cosas [5], así que es posible que lo veas alrededor. No olvides nunca ser honesto. Si no estás preparado para aceptar un mundo distinto a tu hipótesis, mejor no te dediques a esto. La investigación cuesta dinero, que muchas veces viene de los impuestos. No lo malgastes.
Más consejos de abuelo. Busca y aprende de los mejores científicos, y tendrás el privilegio de subirte en los hombros de los gigantes del pasado. En España confluyen los legados de varias eminencias en la historia de la neurociencia. Y es que tan grande es la complejidad del cerebro como pequeña es la familia de neurocientíficos en el mundo. Aquí hay un referente claro, Santiago Ramón Y Cajal (navarro de Petilla de Aragón), considerado internacionalmente el padre de la neurociencia moderna. Recibió el premio nobel en 1906 por proponer que las neuronas son células con principio y final (y no células conectadas sin discontinuidad como decía su enemigo Camilo Golgi, con quien compartió el Nobel [6]).
Hoy, los pupilos indirectos de Cajal son los maestros y directores de varios departamentos en universidades y centros de investigación de la península. Los discípulos de otro gigante, Eric Kandel (premio Nobel en el año 2000 por sentar las bases del estudio molecular de la memoria) también extienden su legado en España (por ejemplo, Ángel Barco en el Instituto de Neurociencias de Alicante, quien dirigió la tesis doctoral de un servidor). Un poco antes, mis inicios científicos en la Universidad de Valencia fueron con Enrique Lanuza, quien se entrenó con Joseph LeDoux, uno de los más grandes investigadores de la amígdala (la parte del cerebro que procesa las emociones). Pero esto no es una lista exhaustiva, hay muchos más ejemplos. Son muchos los que recogen el relevo de todos esos gigantes, búscalos y aprenderás mucho.
Y aunque la cantera sea buena aquí, en algún momento de tu formación tendrás que irte fuera para aprender o inventar lo que aquí ya nadie conoce. En otro país, tendrás que empezar de nuevo en lo personal: nuevos amigos, idioma, costumbres. Será duro, pero en general ganarás. Tu cerebro se enriquecerá en múltiples niveles con esas experiencias. Te sentirás solo, te tratarán como a un extranjero, pero así aprenderás a no tratar como tales a los que a tu país vengan. Lo que aprendas fuera te servirá siempre en tu carrera, y cuando regreses a tu país podrás mejorar la ciencia del lugar donde naciste y devolverle la inversión que en tu formación hizo (si es que vuelves).
En perspectiva, pequeño neurocientífico, sentirás vértigo cuando eches la vista atrás sobre tus pasos, en esta exploración del mayor misterio del universo. Vértigo por contemplar desde tanta altura todo el pasado bajo tus pies sobre los hombros de tantos gigantes que precedieron tu aventura.
"Si he logrado ver más lejos, ha sido porque he subido a hombros de gigantes (Isaac Newton)"
Este texto fue publicado originalmente en SciLogs.es el 14/08/2014:
Referencias:
[3] Agenciasinc
José Viosca
Doctor en Neurociencias
Comunicador Científico
De pequeña la palabra neurociencia no formaba parte de mi día a día, aunque si alguien me hubiese preguntado su significado creo que aun siendo una tierna infante hubiera más o menos acertado con la respuesta: "la ciencia de la cabeza" o algo parecido hubiera contestado. De proseguir la conversación, hubiera explicado a mi extraño interlocutor (¿pero quién pregunta estas cosas a niños chicos?) que la neurociencia debía de ser una ciencia muy importante porque el cerebro, según nos decían en la escuela, aunque feo, viscosillo y arrugado lo controlaba TODO. De manera casi intuitiva mi yo de 8 años hubiera pensado que no se podía ir por la vida siendo un ignorante de la neurociencia (como mi interlocutor que se lo tenía que preguntar todo a una niña pequeña) porque cuanto más supiéramos del cerebro más cerca estaríamos de hacer cosas con la mente como por ejemplo cambiar los canales de la tele sin moverse del sofá,… un potencial uso práctico de la neurociencia que más tarde cayó en el olvido con el advenimiento del mando a distancia. Desafortunadamente nadie me hizo esta pregunta ni con 8 años ni con 16, así que la falta de reflexión temprana retrasó mi vocación hasta bien entrados mis estudios de carrera versados en Bioquímica y otras lindezas. De entre todas las bioquímicas que tienen lugar en la naturaleza, sin duda la que me parecía más apasionante es la química del cerebro o Neuroquímica. En aquellas clases, entre cuchicheo y cuchicheo, aprendí cosas fascinantes pero que lejos de aclararme cómo funcionaba el cerebro me planteaban más y más preguntas, algo que al profesor le debió de llamar la atención por lo que posteriormente me sugirió hacer un doctorado en seguro que adivináis en qué,… pues sí en ¡Neurociencia!,… y hasta ahora sigo con más preguntas que respuestas. En este estado de duda continua me acompañan mis colegas neurocientíficos, una panda de temerarios exploradores que sueñan con descubrir los misterios más misteriosos del cerebro.
Desgraciadamente en la actualidad aun no somos suficientes para resolver el gran problema al que nos enfrentamos. Esto es en parte debido a que la Neurociencia es un campo de investigación relativamente joven en comparación con otras disciplinas como la Biología Celular o la Inmunología. De hecho esta ciencia en gran medida debe su origen al científico español Don Santiago Ramón y Cajal, padre de la Neurociencia moderna y ganador del primer premio Nobel español de Medicina por sus pioneros descubrimientos en la organización del sistema nervioso. Por este origen tan español, la Neurociencia tradicionalmente ha despertado un especial interés en nuestro país y de hecho varios discípulos aventajados de Cajal continuaron su legado realizando nuevos descubrimientos y postulando teorías de gran influencia, a pesar de que en ocasiones contradecían a las del maestro. En palabras de Santiago Ramón y Cajal, "el cerebro es un mundo que consta de numerosos continentes inexplorados y grandes extensiones de territorio desconocido". Con estas palabras Cajal nos sugería que el avance del conocimiento, mucho más allá de sus propias aportaciones, era la clave para comprender los enigmas del cerebro y que por supuesto esos nuevos avances quedarían en manos de las futuras generaciones. Para guiarlos en la ardua tarea de la exploración científica, Cajal escribió un manual titulado "Reglas y consejos sobre investigación científica", que a pesar de ser un poco antiguo (fue publicado en 1897) y no exactamente aplicable a nuestros días contiene muchas ideas interesantes para el joven aspirante a premio Nobel. En la actualidad la Neurociencia vive un momento de gran entusiasmo nacional e internacional (el 2012 fue declarado Año de la Neurociencia en España) ya que nuevos avances tecnológicos están haciendo posible realizar experimentos hasta ahora imposibles y que permitirán a las nuevas generaciones (ósea tú lector sabio e intrépido) resolver muchos de los secretos de la función cerebral. Pero: ¿cuáles son estas preguntas sin responder que quedarán en vuestras manos?, en otras palabras ¿cuáles son los retos de la Neurociencia moderna? A continuación os dejo unas pinceladas de los retos, misterios y aventuras que esperan a los futuros neurocientíficos.
Tres Preguntas de la Neurociencia Moderna para el Neurocientífico del Futuro (no por orden de importancia, pocas pero matonas):
¿Cómo se forma la memoria?
El cerebro humano tiene una capacidad de computación muy superior al de cualquier ordenador actual, por muy sofisticado que sea. Pensad que nuestro cerebro es capaz de retener cantidades ingentes de información que quedan almacenadas durante largos periodos de tiempo dando lugar a los recuerdos de toda una vida. A los 2 años, el cerebro ya ha alcanzado el 80 por ciento de su tamaño adulto, por lo que es lógico pensar que las numerosas experiencias que recordaremos a partir de esta edad no están directamente relacionadas con un aumento de tamaño del cerebro sino con algo más. Los neurocientíficos pensamos que este algo más son cambios que se producen entre las células nerviosas (neuronas) de tal forma que algunas neuronas refuerzan sus conexiones mientras que otras desaparecen en un continuo proceso de cambio. Esta idea asume que el cerebro no es un órgano fijo sino flexible, plástico y en constante proceso de construcción un fenómeno que en Neurociencia se conoce como "Plasticidad Cerebral". En los últimos años los neurocientíficos se han centrado en estudiar este proceso en profundidad y aunque hay muchos indicios, aún no estamos completamente seguros si la plasticidad cerebral es el único proceso que explica no solo el almacenaje y sino también la pérdida de memorias. Y en todo caso ¿cómo funcionaría?, ¿cómo se alteraría en enfermedades que afectan a la memoria?,… tu turno querido lector.
¿Por qué soñamos?
A lo mejor no os lo habíais planteado pero el estudio del sueño es una disciplina muy importante dentro de la Neurociencia, y no me refiero a la interpretación de los sueños en plan siéntate en el sofá y cuéntame que soñaste anoche, no, si no a entender cómo se forman y sobre todo cuál es su función. Porque la función del sueño debe de ser importantísima ya que fijaos que un adulto de unos 70 años habrá pasado como unos ¡20 años durmiendo!, y esto es mucho tiempo para algo sin importancia, ¿no os parece? Aunque el cuerpo durante la noche se encuentre en reposo, el cerebro nunca para ni siquiera mientras dormimos ya que como os podéis imaginar aún es necesario mantener el control de muchas funciones involuntarias como la respiración y el ritmo cardiaco. Debido a que el cerebro nunca se desconecta del todo se piensa que los sueños son un producto de la actividad cerebral presente durante la noche. Los neurocientíficos pensamos que los sueños juegan un importante papel en la formación de la memoria a largo plazo, y que es justo este periodo de inconsciencia es fundamental para seleccionar la información más importante. Pero ¿Cómo la generación de imágenes sin sentido y en ocasiones terroríficas nos ayudan a recordar mejor y aclarar nuestras ideas?
¿Cuál es la mejor manera de estudiar el cerebro?
Pensad en cuando abrís cualquier cacharro para ver que hay dentro, y una vez satisfecha vuestra curiosidad habéis querido recomponerlo y,…pues no había manera: sobran o faltan piezas, los enganches están dados de sí, etc…. Pues aunque os parezca mentira algo muy parecido nos pasa a los neurocientíficos (y científicos en general).

Fig. 1. Imagen de un hipocampo fluorescente.
Queremos ver el cerebro en acción pero como os imaginaréis, la gente no puede ir por ahí con la cabeza abierta para que nosotros veamos lo que está pasando,… nos meteríamos en serios problemas. Por lo tanto en la mayoría de los laboratorios de Neurociencia se usan pequeños fragmentos de cerebro que nos permiten hacer experimentos de manera más sencilla. Sí, es verdad que así evitamos problemas con la justicia, pero luego a la hora de ponerlo todo junto otra vez es un auténtico lío. Por este motivo, uno de los retos de la Neurociencia moderna es también un reto de ingeniería o tecnológico por desarrollar nuevas maneras para estudiar el cerebro en conjunto y en pleno funcionamiento. Esto es muy difícil pero en los últimos años han ido apareciendo técnicas (Imagen Funcional) que nos permiten visualizar el cerebro de gente vivita y coleando sin necesidad de abrirle la cabeza a nadie. Estos avances son muy esperanzadores pero aun presentan muchas limitaciones, ya que los experimentos tan solo pueden realizarse con las personas dentro de un escáner especial que limita sus acciones. Idealmente nos gustaría poder abrir una ventana (siempre imaginaria ¿eh?) a lo que está pasando en el cerebro afectándolo lo menos posible y permitiendo total libertad de movimientos al individuo de estudio. Este reto se solucionara gracias a la colaboración de mucha gente entre otros ingenieros y neurocientíficos, así que aunque lo vuestro en un principio no sea la Neurociencia quién sabe si al final no nos terminamos encontrando en el camino.
Sandra Jurado Sánchez
Doctor en Bioquímica
Científico Titular del CSIC, Instituto de Neurociencias CSIC-UMH
Algunas palabras cuando las oyes por primera vez se guardan con una imagen. ¿Recuerdas la primera vez que escuchaste la palabra célula? La primera vez que vi una célula fue en mi libro de ciencias naturales donde se veía una ameba y un paramecio. La primera parecía un huevo frito y el segundo un pepino peludo. Lo que más me llamaba la atención de aquellos dibujos, era la enormidad de componentes que tenían dentro.
Nuestro profesor nos decía que nosotros estamos hechos de células, de millones de ellas y que a pesar de tener partes comunes, cada una tenía una profesión. Y lo más alucinante, ¡qué todas provenían de una sola! Entonces, me resistía a pensar que estábamos hechos de cosas tan feas y blandas que no se veían. Y tenía preguntas como ¿las plantas que no se mueven, tienen células?, ¿las ballenas o elefantes tienen células mas grandes?, ¿las bacterias y los virus son células?, ¿cuál es la más grande?, ¿y la más pequeña?, ¿cuánto viven las células? Ahora mirando atrás uno recuerda aquel momento como un punto de partida en el que se han enlazado otros para dar significado a lo que me dedico ahora.
¿Qué es una célula?, ¿Por qué se llama célula?
Pero si eran tan pequeñas que no se podían ver ¿cómo las descubrieron? A veces no basta con mentes creativas y desafiantes para formular nuevas hipótesis; en ocasiones, es necesario desarrollar una tecnología que permita probar estas hipótesis. Y esto es lo que ocurrió con el descubrimiento de la célula. La invención del microscopio facilitó la observación del mundo con una nueva perspectiva. Así, el físico Robert Hooke reunió en un libro llamado Micrografía (1665), las primeras observaciones con microscopio, donde se mostraban dibujos de tejidos vegetales. En la corteza de árbol, observó espacios huecos o cámaras que le recordaban a celdas de un monasterio, (refiriéndose a estos como cell) cuyo diminutivo en latín era cellŭla (celdilla). Ahora ya sabes de donde viene el nombre de célula. Sin embargo, Hooke sólo se limitó a describir lo que observó, nunca dijo cuál era el verdadero significado lo que había visto. Mientras, los microscopios iban mejorando y se acumulaban observaciones de este nuevo mundo microscópico en la que se describieron células sanguíneas, espermatozoides y distintos animáculos. Tener a mano las tecnologías más avanzadas no asegura nuevas ideas. Hubo que esperar casi 200 años hasta que dos científicos alemanes Schleiden y Schwann en el año 1839 llegaran a afirmar que todas las plantas y animales están formados células.
Todo organismo vivo está formado por células
A partir de ahí, otros científicos moldearon la "doctrina celular" que se podría resumir en cuatro ideas: 1) todos los organismos están formados por células; 2) las células provienen tan sólo de otras preexistentes 3) las células contienen el material hereditario y 4) en las células se producen las reacciones metabólicas del organismo. Algo tan sencillo tardó esos doscientos años en concretarse. Si miramos alrededor, hay organismos de una sola célula (uni-celulares) como las bacterias o las levaduras y otros con varias células (pluri-celulares) como el alga Tetrabaena con cuatro células, el nematodo C. elegans (un tipo de gusano) con 959 células o con millones de millones de células como en una ballena; y los dinosaurios ¿cuántas tendrían? y ¿nosotros? En nuestro caso, no está claro, lo único que podemos hacer es aproximarnos a una cifra. Se estima que nuestro cuerpo puede estar formado por unos 37 billones (37 multiplicado 1,000,000,000,000 de células, aunque investigadores consideran que tenemos entre 5 y otros 200 billones ¿es que no hay una cifra exacta como la del gusano? Por ahora no, pero esperamos que alguien sea capaz de resolver el enigma. Y si hay tantas células ¿cuántos tipos de células hay? Pues sólo se han descrito unos 200 tipos celulares, pero esto no significa que se hayan descrito todos los tipos de células. Hay tipos celulares de las que no sabemos nada y por ello en la actualidad un grupo de investigadores (citólogos, bio-informáticos, clínicos, etc…) se dedican a crear un atlas de las distintas células humanas que sirva de base para la investigación y tratamiento para enfermedades. Si se considera a la célula como el organismo de menor tamaño que puede considerarse vivo, ¿cuál es la mayor y menor célula conocida? La más grande del ser humano es el óvulo femenino (lo siento, chicos) con un tamaño de alrededor de 1 milímetro, y que puede ser visible sin instrumentos (aquellos que tenga buena vista, claro) y en la naturaleza uno pensaría igualmente que el huevo de la avestruz (con unos 15 centímetros), pero… hay otros organismos con células más grandes, por ejemplo, las neuronas de la jirafas, o las de los calamares gigantes que podrían alcanzar un tamaño de 12 metros (80 veces más grande que el huevo de avestruz). ¿Y la más pequeña? En nuestro cuerpo, la disputa está entre las células granulares del cerebelo (4-4,5 micras) y los espermatozoides (lo siento, chicas) con 3 micras, aunque recuerda que tiene una cola llegando hasta las 25 micras. Pero las células más pequeñas conocidas son las bacterias llamadas micoplasmas, con menos de una micra (alrededor de 0,3 micras) y con un peso similar a 8 mil millones de átomos de hidrogeno ¿Y un virus? ¡Es aun más pequeño! Los virus aun siendo más pequeño que las bacterias, son consideradas por la comunidad científica como organismos no vivos. Sin embargo, este debate aun permanece y algunos autores consideran a los virus como organismos en el límite de la vida. Serían como "zombies celulares". Según los puntos que hemos visto antes un virus presenta propiedades como las de las células, como poseer información genética que le permiten reproducirse (provienen de otros virus) y evolucionar por selección natural. Pero… no tienen metabolismo, por lo que necesita para su supervivencia la maquinaria metabólica de una célula. ¿Crees que esta discusión está cerrada? Se han descubierto unos virus gigantes (llamados girus) que tienen un tamaño similar a bacterias pequeñas que podrían descender de un antepasado muy primitivo de antes de que evolucionaran las células eucariotas o incluso estar presente en los tiempos de LUCA, ¿quién es LUCA? (viene del inglés, "last universal common ancestor"), pues el primer ancestro común de todos los organismos fosilizados y presentes. Todos estos hallazgos y discusiones hacen que se presenten nuevas hipótesis que precisan nuevos datos que aclaren que ocurrió en el pasado. ¿Te animas?
Célula equilibrista
Como te he descrito, la diferencia entre los virus y las células, es que en las células se producen las reacciones metabólicas. Seguramente ya conoces algunos de estos procesos celulares, como la fotosíntesis, la síntesis de azúcares, etc… y a lo que se dedican bioquímicos y biólogos moleculares; descubrir nuevas moléculas y la función que desempeñan para permitir la supervivencia de organismos como nosotros. No todo tiene que ser encontrar nuevas moléculas, hay muchas moléculas cuya función se conoce pero es desconocida la relación con otras moléculas o las vías celulares en las que participan. Pero para esto, no necesitas estar metido en un laboratorio. Con los datos que ya se conocen, hay investigadores que gracias a la potencia actual de la informática, se dedican a estudiar cual sería el resultado de si cambio esto o aquello en una vía celular simulada en nuestras computadoras. ¡Es la nueva biología molecular!, mezcla de experimentación de laboratorio y tu ordenador. Todas estas reacciones metabólicas mantienen al final las condiciones de la vida del organismo constantes, ya seas unicelular o tengas billones de células, como nosotros. En nuestro organismo, cada segundo, se busca mantener un equilibrio interno que lo aleje de situaciones de riesgo. Es lo que llamamos homeostasis. ¿Y por qué este interés con el equilibrio celular? ¿Qué ocurre cuando esto falla? Cuando este equilibrio falla, produce un mal funcionamiento de la célula y hasta su muerte, y en organismos como nosotros la aparición de enfermedades.
La muerte celular es esencial
Entones, para evitar enfermedades lo mejor es evitar que lleguen a morir las células ¿verdad? En unos caso sí en otros, no. La muerte celular es un proceso normal en nuestro organismo.

Fig. 1. ¡Es la nueva biología molecular!
Cada segundo, alrededor de 1 millón de células mueren en tu cuerpo ¿tantas? y ¿cuáles? Por ejemplo, las células de las paredes de tu intestino, pulmones o células sanguíneas se renuevan continuamente. Esta es una de las razones por la que es difícil saber el número exacto de células totales en nuestro organismo. Entonces, ¿cuánto tiempo viven nuestras células? pues depende del tipo de célula, si es una del tipo sanguíneo, no mucho, entre horas y días otras, como las musculares unos 25 años, mientras que las células madre o algunas de tus neuronas estarán contigo toda tu vida. Y ¿por qué mueren? Ante un ataque físico o químico, las células aguantan el equilibrio hasta un punto en el que no pueden más y se produce su muerte, pero lo habitual es que las células antes de llegar a ese punto, inicien un programa de autodestrucción. Lo has leído bien, todas las células de nuestro cuerpo tienen preparado un plan para "suicidarse". Si quitamos los accidentes ¿quién ordena este suicidio celular? pues… tu propio cuerpo. Recuerda que somos organismos pluricelulares y si, por el bien del grupo, es preciso la eliminación de unas células, ten seguro que se sacrificarán. Las células tiene este sistema de autodestrucción a punto. Por ejemplo, en el desarrollo de nuestro cuerpo se generan células que en el futuro organismo, en la forma madura, ya no son necesarias. Cuando somos fetos, nuestros dedos están unidos por una membrana de células (como en la pata de un pato) que se elimina al nacer, dejando nuestros dedos separados. Nuestro cerebro en desarrollo produce más neuronas de las que después quedan en el cerebro adulto, siendo la conexión entre las neuronas lo que determina su supervivencia. Y este suicidio ¿ocurre en todos los organismos?, y ¿en los unicelulares también? Estos no tendrían por qué suicidarse ¿verdad? Aunque no lo creas, este suicidio celular también se ha observado en organismos como en bacterias, lo que indica que este proceso se inició muy temprano en la evolución de la vida, si bien su finalidad, los mecanismos y elementos (enzimas, señales, etc.) implicados aún no están claros y requieren nuevas ideas. Y si se alteran los procesos de muerte celular ¿qué sucede? Cuando las células cambian los mecanismos de control para evitar este suicidio, los resultados finales pueden producir enfermedades como el cáncer o la autoinmunidad (nuestro cuerpo se ataca a sí mismo). Pero, si la muerte de las células se produce dónde y cuándo no debe, puede originar daños en el organismo como enfermedades cardiacas o del sistema nervioso. Como ves, controlar el proceso de muerte celular es importantísimo.
Mil maneras de morir y un entierro
No todas las células se suicidan de la misma forma. Dependiendo del tipo celular o del daño que sufra la célula, ésta responde para protegerse, pero si no puede, inicia uno o varios programas de suicidio celular, como apoptosis, necroptosis, paraptosis, autofagia, catástrofe mitótica, etc.

Fig. 2. Suicidio Celular.
Aún se discute cuales son las características que definen a cada tipo de suicidio, pero es difícil, porque las moléculas que lo desencadenan pueden participar en varios tipos distintos. Así, cuando estudiamos estos procesos normalmente encontramos un cadáver celular con un tarro de veneno, un puñal clavado, una soga, etc.… y lo único cierto es que está muerta y… que tendrá un entierro. Sí, un entierro, porque si no se eliminan correctamente sufriremos de nuevo enfermedades. En este punto, te diré que hay dos tipos de investigadores que trabajan sobre la muerte celular: los asesinos profesionales y los guardaespaldas. Los primeros intentan eliminar sólo a aquellas células que se resisten a morir cuando deberían hacerlo y no hacen más que generar problemas al organismo que lo aloja, como en el cáncer. Una curiosidad ¿sabías que las ballenas o elefantes con mil veces más de células que nosotros tienen menos riesgo de sufrir cáncer? Pero no toda célula que se resiste a morir supone la formación de cáncer. Las células se pueden convertir en zombies, que no se dividen pero que se niegan a morir, favoreciendo el envejecimiento. Si eliminas estas células zombies, los animales rejuvenecen ¿es este el futuro de la cosmética? Los guardaespaldas hacen lo contrario. Recuerda que hay células, como neuronas, que necesitas toda tu vida y es muy difícil sustituirlas, por eso hay que buscar la mejor forma de evitar que la célula se suicide (enfermedades neurológicas). Cuando en un accidente tu sistema nervioso se ve afectado, muchas células neuronales sanas, con el ambiente tóxico que se genera tras el daño, se les ordena que se suiciden. De ahí nuestro esfuerzo para desarrollar terapias moleculares que protejan solamente a las células sanas del ambiente tóxico y evitar su suicidio. Pero para ello, necesitamos conocer cuáles son las vías y elementos moleculares que producen estas muertes programadas para ofrecer las mejores terapias y queda tanto por saber… ¿Te animas?
Rodrigo Martínez Maza
Doctor en Bioquímica y Biología Molecular
Grupo de Neuroprotección Molecular
SESCAM, Hospital Nacional de Parapléjicos
Todos nos hemos preguntado alguna vez ¿Quiénes somos? ó ¿De dónde venimos? Si bien ambas preguntas fueron en gran parte respondidas por Darwin y Wallance en el siglo XIX, las pruebas más contundentes a estas cuestiones, las buscan y estudian los paleoantropólogos.
La Paleoantropología o Paleontología Humana es la disciplina científica que estudia el origen y evolución del Hombre a través del registro fósil. Es una rama más de la Paleontología, ciencia que estudia a los organismos (Biología) que vivieron en el pasado, por medio de los fósiles y que aparecen en las rocas (Geología). Es por ello, que la Paleontología, se encuentra a caballo entre ambas ciencias. Generalmente, los paleoantropólogos se forman en las titulaciones de Biología y/o Geología. No obstante, y más en los últimos años, la Paleoantropología debe apoyarse en muchas disciplinas: Arqueología, Geocronología, Paleogenética, Antropología, Climatología, Primatología, Anatomía y otras más.
El trabajo inicial del paleoantropólogo es el de Campo, en concreto en los yacimientos, en donde mediante el estudio y preparación muy pormenorizada de los mismos: dibuja, fotografía, georeferencia, consolida, extrae y sigla los fósiles que más tarde en el laboratorio serán estudiados con un grado de detalle y minuciosidad extrema. Estos trabajos se realizan de rodillas, en cuclillas o incluso tumbados, sumando además las condiciones ambientales del entorno: calor, frío, humedad.
Además, en algunos yacimientos situados en cuevas, el acceso implica bajar por grutas muy estrechas, pertrechados con ropa de espeleología. Yacimiento como la Sima de los Huesos (Atapuerca) es un claro ejemplo de estas condiciones.

Fig. 1. Yacimiento de la Gran Dolina (Atapuerca-Burgos)
Si los fósiles que encuentra se parecen a nuestros huesos y/o a nuestros dientes, el paleoantropólogo puede tener las primeras pistas de que ha encontrado un antepasado nuestro, un verdadero fósil humano. En concreto se buscan aquellos huesos relacionados con nuestra forma de desplazarnos (sobre dos piernas) y que es el rasgo que más nos distingue a nosotros y a nuestros antepasados directos, de otros mamíferos y de los grandes simios. También algunos rasgos de nuestros dientes son las pistas más concluyentes para clasificar al fósil como humano. Es por ello que el paleoantropólogo debe conocer mucho nuestra anatomía ósea, es decir nuestro esqueleto, porque serán los fósiles de los huesos lo que (si hay suerte) encontrará en los yacimientos.
Excepcionalmente fosilizan otras evidencias de la vida de nuestros antepasados: las pisadas o huellas (icnitas) son un ejemplo. Las huellas fósiles humanas más famosas del Mundo son las de Laetoli (Tanzania), con una antigüedad de 3,2 millones de años, se trata de un rastro de entre 2 ó 4 individuos que caminaron sobre ceniza volcánica humedecida. Este rastro fósil, nos confirmó que nuestro caminar ya estaba desarrollado en nuestros antepasados los Australopithecus. Las piedras talladas, también son otras pruebas de la vida de nuestros antepasados y que encontramos en los yacimientos paleoantropológicos, ahora bien, estas son estudiadas por los Arqueólogos. Las más antiguas halladas hasta ahora, tienen una edad de 2,4 millones de años.

Fig. 2. Equipo del MNCN-CSIC analizando fósiles del yacimiento del Sidrón (Piloña, Asturias)
El trabajo de Laboratorio comienza con la extracción de los fósiles de sus embalajes, bolsas, recipientes, etc. Una vez el fósil liberado de su envoltorio que lo preserva durante el transporte al laboratorio, se estudia utilizando para ello todo tipo de medios y tecnologías a su alcance: Tomografías, microscopios, escáneres, etc., a partir de su estudio en detalle, a veces recomponiendo piezas de distintas campañas de excavación, podemos obtener un buen fósil; por ejemplo: un cráneo en el que poder analizar todos sus rasgos y formular hipótesis de su vida y las relaciones de parentesco con otras especies. Estos hallazgos y todo su estudio, que puede durar años, se publican en revistas científicas.
Una de las publicaciones más relevantes a nivel mundial realizada en España sobre Paleoantropología, se produjo en la revista Science en el año 1997 cuando el equipo de Atapuerca publicó el estudio de fósiles de una especie jamás descubierta; fue por ello que propusieron un nuevo nombre a nuestro árbol evolutivo: Homo antecessor. Además, aquel hallazgo supuso el retrasar la presencia de homininos en Europa, hasta los 780.000 años. Hoy en día se piensa que los homininos llegaron a Europa hace algo más de un millón de años.
Los paleoantropólogos aplican mucho el "Actualismo", es decir observan la naturaleza actual para intentar explicar y formular hipótesis sobre la vida de nuestros antepasados, ya que como ya dijimos, sólo encontraremos: huesos, dientes, piedras talladas, huesos de animales consumidos, fuegos, huellas y/o coprolitos. Además, aparecen incompletos y deteriorados. Así, un buen paleoantropólogo debe conocer el comportamiento (etología) de las especies animales más emparentados con nosotros y que son los grandes simios: Chimpancés, Gorilas y Orangutanes. Aprender de sus costumbres y comportamientos, para plantear (con la información de los fósiles) hipótesis sobre la vida de nuestros antepasados.
También deberán conocer muy bien la anatomía de estas especies para compararla con los fósiles hallados y con nuestro propio esqueleto. De esta manera, suelen llamar caracteres "primitivos" a aquellos rasgos que presentan los fósiles más parecidos a estos simios y caracteres "modernos" a aquellos rasgos que presentan los fósiles y que son similares a los nuestros.
Recientemente de algunos fósiles humanos se ha podido obtener ADN que quedó preservado en los huesos. Yacimientos españoles como el del Sidrón es un referente mundial de recuperación y estudio de ADN fósil neandertal. También en nuestro país, los fósiles humanos más antiguos en donde se ha podido obtener ADN son los del yacimiento de la Sima de los Huesos (Atapuerca) de hace 430.000 años.
Antepasado más antiguo
Siendo rigurosos habría que remontarse al comienzo de la Vida, ya que estamos relacionados por Evolución con todos los grupos biológicos que han poblado la Tierra.

Fig. 3. Cráneo de Sahelanthropus tchadensis vivió hace 6,8 a 7,2 m.a.
De hecho, nuestra clasificación comienza con el Reino de los Animales continua con el Filum de los Cordados, la Clase de los Mamíferos, el Orden de los Primates, la Familia de los Homínidos, la Tribu de los Homininos, etc., será en esta última subdivisión, donde suelen trabajar la mayoría de los paleoantropólogos.
La genética nos dice que humanos y chimpancés (la especie viva más emparentada con nosotros) tuvimos un antepasado común que vivió hace entre 7 y 5 millones de años. A partir de ese momento, cada linaje llevó su camino evolutivo. Es por ello que si queremos encontrar fósiles de nuestros antepasados más directos (llamados homininos) deberemos buscarlos en rocas con edades de entre 7 millones de años y la actualidad…, y ¡Eureka! en el año 2002 se publicó el hallazgo de un cráneo y unos pocos dientes de un fósil en Chad (África) al que se llamó Sahelanthropus tchadenis en rocas de esa edad y con rasgos más humanos que de chimpancé, por lo que hoy en día es considerado nuestro antepasado más antiguo.
Especies descubiertas
Aunque no hay acuerdo por parte de los paleoantropólogos, aproximadamente, se han catalogado unas 28 especies de homininos (todas extinguidas menos nosotros); si bien para simplificar la terminología, yo recomiendo tratar este grupo a nivel de Género. Así, se han clasificado 7 géneros, de más antiguo a más moderno y con su cronología en millones de años (m.a.): Sahelanthropus (7,2-6,8 m.a.), Orrorin (5,8-6 m.a), Ardipithecus (5,2-4,3 m.a), Australopithecus (4,2-1,8 m.a), Kenyanthropus (3,5-3,2 m.a), Paranthropus (2,7-1,2)y Homo (2,4-Actualidad).
Árbol evolutivo
Tampoco hay consenso en este aspecto, por lo que hay varias propuestas. Sin embargo, sí están todos de acuerdo en que nuestro árbol es muy ramificado, nada que ver con la secuencia de evolución lineal que todos hemos visto alguna vez en libros y publicaciones poco científicas (Fig. 4 izda.). De hecho, nuestro árbol se parece mucho a un arbusto con muchas ramas, quedando hoy en día solo nuestra rama. (Fig. 4 dcha.). A esta conclusión se ha llegado porque son muchas las especies descubiertas que coexistieron en los mismos periodos y a veces en los mismos hábitats; descartando así una evolución lineal. Nuestro árbol evolutivo no es muy distinto al de otras especies de mamíferos.

Fig. 4. Recreación errónea de nuestra evolución (izda.) y árbol evolutivo científico (dcha.) Dr. Ian Tattersall
Yacimientos y Museos españoles con temática en Evolución humana
Hay muchos yacimientos visitables, os recomiendo los siguientes: Atapuerca (Burgos), Orce (Granada), El Castillo y Altamira (Cantabria), Ambrona y Torralba (Soria), Tito Bustillo (Asturias) y El Valle de los Neandertales (Madrid).

Fig. 5. Museo de la Evolución Humana en Burgos
Museos o centros de interpretación con contenido de Evolución humana, hay menos, pero los siguientes son muy recomendables: De la Evolución Humana (Burgos) es el más importante por su contenido exclusivo en nuestra evolución, Nacional de Ciencias Naturales, Arqueológico Nacional, Regional de Madrid (Madrid), Centro de Investigación de Altamira, De Prehistoria y Arqueología de Cantabria (Santander).
Para saber más:
[1] Arsuaga, J.L y Martínez, I. (1998): La especie elegida. Temas de hoy.
[2] Bermúdez de Castro, J.M. y otros (2004): Hijos de un tiempo perdido. Crítica.
[3] Rosas, A. (2015): Los primeros homininos. Los Libros de la catarata.
[4] Rosas, A. (2016): La evolución del género "Homo". Los Libros de la catarata.
Andrés Armendáriz Sanz
Licenciado en Ciencias Geológicas especialidad de Paleontología U.C.M. Divulgador científico en Evolución Humana. Miembro de los proyectos Geodivulgar y Ciencia Sin Barreras U.C.M, de la Asociación Española para la Enseñanza de las Ciencias de la Tierra (AEPECT), socio del Museo de la Evolución Humana y de la Fundación Atapuerca y socio de la Sociedad Geológica de España (SGE).
Todos tenemos libros, películas o momentos que nos marcan de pequeños, y que de alguna manera contribuyen a definir a qué dedicaremos nuestros intereses lúdicos o profesionales durante nuestra vida.

Fig. 1. El clima es un factor determinante a la hora de moldear los diferentes ecosistemas que existen a lo largo del planeta.
En mi caso fue un poco de todo; la película "La misión" y la trilogía "Indiana Jones" despertaron mi interés por la exuberancia del trópico sudamericano y los tesoros que esconde de tiempos pasados. Y las salidas de fines de semana con mi padre por el campo murciano mientras él buscaba sus palomos de colombicultura me permitieron pasar mucho tiempo al aire libre y desarrollar un rasgo que ha marcado mi vida hasta ahora: la curiosidad. Así, en el monte, me di cuenta de que allí fuera había muchas cosas: animales, plantas, rocas, etc., y que todas existían de manera independiente, pero a su vez se relacionaban entre sí e influían los unos en los otros. Y así es cómo, poco a poco, me fui dando cuenta de a qué quería dedicarme: quería saber cómo funcionan los ecosistemas, por qué cambian con el tiempo y qué es lo que hace que cambien.
¿Qué es la paleoecología?
La paleoecología es la parte de la ecología que se encarga de estudiar los ecosistemas pasados o el pasado de los ecosistemas actuales. Este trabalenguas de definición viene a referirse simplemente al significado de las partes que componen la palabra: paleo (pasado) y ecología (estudio de las interacciones entre los organismos y el ambiente en el que viven). Así, la paleoecología estudia las relaciones entre organismos que existieron en el pasado y sus relaciones con el ambiente en el que vivieron, es decir, cómo eran los ecosistemas hace miles o millones de años. Al igual que a día de hoy un ecosistema mediterráneo es muy diferente de uno amazónico como resultado de los diferentes factores bióticos y abióticos que operan en ellos (Fig. 1), los ecosistemas de un lugar determinado han ido cambiando a lo largo del tiempo. Por ejemplo, el paisaje que viví yo junto a mi padre es radicalmente diferente al paisaje que caracterizó Murcia en la edad de hielo, hace unos 22.000 años atrás. Por lo tanto, la paleoecología implica también estudiar cómo han ido cambiando estos ecosistemas pasados a lo largo del tiempo hasta llegar a lo que nosotros vemos hoy en día, y qué ha hecho que éstos cambien. Entre los factores más comunes que modifican los ecosistemas a nivel global se encuentra el clima y el hombre, pero también otros como las erupciones volcánicas, la aparición de nuevas especies o las extinciones en masa. Pero, volviendo a la definición del principio ¿cómo se puede estudiar algo que ya no existe? Para eso los paleoecólogos utilizamos nuestra propia máquina del tiempo.
¿Cómo se trabaja en paleoecología? En busca de la máquina del tiempo
Por suerte para los paleoecólogos, el planeta está lleno de pistas de cómo han sido sus ecosistemas a lo largo de la historia.
Al igual que nuestro médico tiene un registro con todos los incidentes de salud que nos han ocurrido desde que nacemos, la Tierra también ha ido almacenando esa información en distintas partes del mundo a la espera de ser desvelada. Es lo que se conoce como el registro geológico.
Dentro de este registro, encontramos información sobre una multitud de características tanto del funcionamiento del planeta, como de los ecosistemas que existieron y de los organismos que vivieron en él. La función de una paleoecóloga es encontrar dónde están almacenadas esas pistas, recolectarlas y descifrarlas. Entre los tipos de registros más usados en paleoecología están los archivos sedimentarios, o lo que es igual, zonas de acumulación de material orgánico y mineral como las cuencas de los lagos o las turberas donde las diferentes pistas se depositan y quedan conservadas.
Lo magnífico de estos sedimentos es que captan las pistas y las almacenan de manera ordenada en el tiempo.
Así, la información de los alrededores de un lago en el día de hoy se deposita y conserva en una capa de sedimento, las de mañana se depositarán en una capa encima de ésta, y así sucesivamente como lo harían las capas de una tarta (Fig. 2).
De manera que lo que se obtiene son diferentes capas de sedimento con una edad determinada que contienen multitud de pistas acerca de cómo era el ecosistema en ese momento.

Fig. 2. A través de plataformas flotantes se recogen los sedimentos y los indicadores conservados en ellos acumulados durante miles de años en las cuencas de los lagos. Son nuestras máquinas del tiempo.
A través del análisis de esas pistas, podemos saber cómo eran los ecosistemas desde el pasado (capa más profunda del sedimento) hasta el presente (capa más superficial). Las pistas son muchas y muy variadas; desde las mismas propiedades físico-químicas del sedimento que pueden indicar características del clima, hasta restos microscópicos de organismos que no se descomponen con el paso del tiempo y por tanto son capaces de quedar preservados en el sedimento, conocidos como microfósiles. Las pistas, llamadas parámetros o indicadores, funcionan como las piezas de un puzle, siendo el dibujo del puzle el ecosistema pasado que se quiere reconstruir. Lamentablemente, no todos los organismos fosilizan y dejan huellas de su presencia, por lo que, a la hora de interpretar ecosistemas pasados, el paleoecólogo necesita usar sus aptitudes detectivescas para, mediante la recolección del mayor número de pistas posibles, reconstruir el dibujo del puzle incluso sin llegar a tener todas las piezas.
¿Para qué sirve la paleoecología?
Conocer cómo han ido variando los ecosistemas a lo largo del tiempo es fundamental para multitud de problemas ambientales a los que la humanidad tiene que enfrentarse a día de hoy. Por ejemplo, estudiar cómo responden frente a impactos o perturbaciones en el pasado nos revela la vulnerabilidad de los diferentes sistemas ecológicos. Saber si un sistema es capaz de resistir determinados impactos es clave a la hora establecer los planes de manejo y conservación de los ecosistemas. Por otro lado, si se sabe las especies que existían antes de que se produjera un impacto por la acción del hombre como un vertido, o de una catástrofe natural como una erupción volcánica, se pueden diseñar las estrategias de restauración oportunas para restablecer el ecosistema natural que existía antes del impacto. Al restaurar las especies propias de la zona, aseguramos el mantenimiento de los llamados servicios ecosistémicos, que son todos aquellos productos de utilidad para el ser humano que se obtienen de un determinado ecosistema. Un aspecto muy importante que nos proporciona el conocer las dinámicas de los ecosistemas en el pasado es su aplicación predictiva. Si identificamos las respuestas de los ecosistemas a determinados cambios ambientales que ocurrieron en el pasado, podemos conocer cómo sería la respuesta frente a los mismos cambios en el futuro. Así, como mencionaba al principio del capítulo, durante la historia de la Tierra el clima ha cambiado en multitud de ocasiones. Esas variaciones pueden provocar cambios en los ecosistemas, como por ejemplo la migración de especies a zonas donde el clima era más adecuado y la llegada de nuevas especies más adaptadas al clima reinante. Todos esos cambios, tanto del clima como de la respuesta de los ecosistemas, se han quedado registrados en los archivos sedimentarios. Por lo tanto, los estudios paleoecológicos son capaces de proporcionar estimaciones basadas en datos empíricos de cómo afectará el presente cambio climático, con un aumento en la temperatura global predicho de varios grados centígrados a lo largo de este siglo, a los diferentes ecosistemas actuales y las especies que habitan en ellos. Cabe mencionar el significado de la magnitud que suponen un par de grados a nivel mundial: la diferencia de temperatura mundial de la última edad de hielo, cuando los mamuts lanudos campaban libremente por España, con respecto a la que tenemos en la actualidad es de alrededor tan solo unos 5-9 grados. Es un ejemplo claro de que un par de grados de temperatura de más o de menos puede modificar (¡y mucho!), los ecosistemas de todo el mundo.
Regreso al futuro
La paleoecología usa para conocer el pasado el principio del uniformismo formulado por James Hutton a finales del siglo XVIII, que se resume en que las leyes naturales y los procesos operan de la misma manera a través del tiempo. Posteriormente, Charles Lyell a principios del siglo XIX lo redefinió dentro del mundo geológico estableciendo que el presente es la clave para poder interpretar el pasado. Como paleoecólogos, mis colegas y yo vamos un paso más allá y resumimos nuestra contribución a conocer la historia ambiental de la tierra mediante el axioma: el pasado es clave para conocer el futuro. Para conocer por tanto nuestro futuro, sólo tenemos que usar nuestras máquinas del tiempo e ir en busca de la multitud de piezas de puzle que hay disponibles repartidas por toda la Tierra esperando a ser descubiertas.
Encarni Montoya
Doctora en Biología
Investigadora Postdoctoral
Instituto de Ciencias de la Tierra Jaume Almera
Seguramente nadie (en su sano juicio) habrá pronunciado esta frase cuando empieza a pensar hacia dónde encarrilar su vida. Paleomagneta no entra dentro de las profesiones comunes en las que uno piensa. Yo llegué a paleomagneta después de estudiar geología. Sí que hubo un día en el que pensé "y yo quiero ser… geóloga!" y una cosa llevó a la otra. Estudié geología porque de repente sentí una gran curiosidad por entender cómo funcionaba ese sitio sobre el que tenía los pies… Y así durante la carrera aprendí cómo se formaban las montañas o se juntaban y separaban los continentes, abriendo y cerrando a la vez océanos y mares, por qué había distintos tipos de rocas o cómo funcionaban los volcanes y porqué estaban en sitios concretos del planeta. Y cuando, finalmente, me adentré en el paleomagnetismo, descubrí una rama de la ciencia que respondía también muchas de las preguntas sobre el funcionamiento de nuestro planeta: CUÁNDO se ha formado una cordillera, CÓMO era el campo magnético de la Tierra en el pasado o DÓNDE estaba un continente hace varios cientos de millones de años (el paleomagnetismo fue fundamental para el desarrollo de la teoría de la tectónica de placas). El Paleomagnetismo tiene muchas aplicaciones, pero yo me voy a centrar en su aplicación para responder al CUÁNDO mediante una de sus ramas, la magnetoestratigrafía. Pero vayamos por partes…
¿Qué es el Paleomagnetismo?
El Paleomagnetismo es el estudio del campo magnético de la Tierra registrado por las rocas. Las bases del Paleomagnetismo son, por un lado, que la Tierra genera un campo magnético que cambia su intensidad y dirección tanto en el espacio como en el tiempo y, por otro, que algunos minerales en la naturaleza pueden comportarse como imanes, es decir, mostrar una magnetización espontánea. Estos minerales magnéticos constituyen una pequeña fracción de los componentes totales de las rocas. Sin embargo actúan como pequeñas brújulas que se orientan según el campo magnético existente en el momento de formación de la roca y además son capaces de conservar esta magnetización durante millones de años. Por lo tanto, estudiando ese magnetismo fósil seremos capaces de saber cómo era el campo magnético cuando se formó la roca y podremos utilizar esa información para, entre otras cosas, saber la edad de una secuencia de rocas.
¿Cómo es el campo magnético terrestre?
El campo magnético terrestre se origina por el movimiento de convección del núcleo externo de la Tierra, que está formado por minerales ricos en hierro y se encuentra en estado semilíquido. En la superficie de la tierra, el campo magnético tiene una expresión dipolar o, dicho de otra forma, muestra dos polos de signo opuesto en los dos extremos del planeta.
Tenemos que imaginar el campo magnético como originado por un imán muy grande centrado en el eje de rotación de la tierra (Fig. 1). Los cambios del campo magnético ocurren a diferentes escalas temporales, desde milisegundos o días como en el caso de las tormentas magnéticas, a variaciones de dirección e intensidad en el rango de décadas o siglos como en el caso de la variación secular, a variaciones en la escala de los miles y millones de años en las que los dos polos magnéticos intercambian su posición, el polo norte magnético pasa al polo sur y a la inversa, en lo que conocemos como inversiones magnéticas (Fig. 1).
La configuración actual en la que el polo sur del dipolo coincide con el polo norte geográfico se conoce como estadio de polaridad normal y el caso inverso, con el polo sur del dipolo cerca del polo sur geográfico se conoce como estadio de polaridad inversa (Fig. 1).

Fig. 1. Campo magnético terrestre e inversiones de polaridad. El registro de las inversiones de polaridad ha dado lugar a la Escala de Tiempo de Polaridad Geomagnética (ETPG), la cual puede usarse para saber la edad de una secuencia de rocas. Figura modificada de Langereis et al., (2010)
Estas dos configuraciones se han ido alternando de manera aleatoria multitud de veces a lo largo de los millones de años de historia de la Tierra. La última inversión ocurrió hace unos 700.000 años. Las inversiones de polaridad tardan aproximadamente 10.000 años en producirse, puede parecer mucho tiempo, pero a escala geológica se considera que es un fenómeno global casi instantáneo. El carácter global y aleatorio de las inversiones es precisamente lo que les confiere utilidad como herramienta de datación.
¿Cómo podemos usar el campo magnético para datar? La Escala de Tiempo de Polaridad Geomagnética (ETPG) y la magnetoestratigrafía
El descubrimiento de las anomalías magnéticas del fondo oceánico proporcionó un registro sin precedentes de inversiones geomagnéticas que podían datarse desde la actualidad hasta el Jurásico Superior (hace 155 Ma).Durante la expansión oceánica, el material del manto asciende por la dorsal oceánica y se solidifica formando nueva litosfera oceánica a ambos lados de la dorsal.

Fig. 2. Formación de las anomalías magnéticas del fondo oceánico (figura modificada de Butler, 1992). Las porciones negras de la corteza oceánica representan polaridades normales y las porciones blancas corresponden a polaridades inversas, todas adquiridas durante el enfriamiento de la corteza oceánica.
La corteza oceánica que forma la parte superior de esta litosfera está compuesta por rocas, mayoritariamente basálticas, que contienen minerales magnéticos que cuando se enfrían se magnetizan y orientan según el campo magnético terrestre. Por lo tanto, esta corteza oceánica va registrando los cambios de polaridad magnética de manera simétrica a ambos lados de la dorsal (Fig. 2). El registro de estas inversiones magnéticas ha dado lugar a un "código de barras" que constituye la base para la construcción de la escala de tiempo de polaridad geomagnética (ETPG).La transformación a edades absolutas (en Ma) de los perfiles de anomalías magnéticas del fondo oceánico se realiza mediante un número seleccionado de edades radiométricas. El intervalo de tiempo de polaridad geomagnética constante se denomina cron de polaridad y se representa en la ETPG como una barra negra cuando es de polaridad normal y como una barra blanca cuando es de polaridad inversa (Fig. 1 y 2). La duración de los crones varía de los 30000 años a varias decenas de millones de años.
El hecho de disponer de una ETPG con las edades de los crones calibradas permite la datación de secuencias estratigráficas. La magnetoestratigrafía se basa en la capacidad de las rocas de adquirir y conservar una magnetización paralela a la dirección del campo magnético terrestre presente cuando éstas se forman. En la datación magnetoestratigráfica identificaremos "magnetozonas" (porciones del registro estratigráfico con igual polaridad magnética) en el registro sedimentario y las correlacionaremos con crones geomagnéticos de edad equivalente.
¿Cómo se obtiene el patrón de magnetozonas? Muestreo y medida en laboratorio
El patrón de magnetozonas se obtiene midiendo la magnetización de las muestras que se recogen en el campo a lo largo de una o varias secciones estratigráficas. Un estudio magnetoestratigráfico requiere obtener muestras de roca en intervalos aproximadamente regulares a lo largo de la serie sedimentaria que queremos datar. El espaciado entre muestras debe permitir identificar todas las inversiones registradas a lo largo de la secuencia sedimentaria. El método de muestreo paleomagnético más generalizado es la perforación y posterior orientación de cilindros de roca en el campo (Fig. 3). Las muestras se perforan en el campo mediante una perforadora eléctrica (Fig. 3a) o de gasolina (Fig. 3b) refrigerada con agua y se orientan en el campo, marcando la dirección de perforación sobre el cilindro que acabamos de perforar (Fig. 3c, d). En el laboratorio las muestras se someten a lo que llamamos desmagnetización progresiva que es como un lavado magnético en el que vamos borrando las señales magnéticas que ha ido registrando la roca a lo largo de su historia para quedarnos con la más estable y que suele corresponder con la adquirida en el momento de formación de la roca.

Fig. 3.Muestreo paleomagnético con perforadora eléctrica (a), de gasolina (b) y orientación de las muestras en el campo (c) y (d).
Una vez obtenida la dirección paleomagnética podremos calcular la polaridad magnética en función de la posición estratigráfica de cada muestra definiendo así magnetozonas que formarán la magnetoestratigrafía local. En general, las magnetozonas se definen a partir de un mínimo de dos niveles estratigráficos consecutivos de igual polaridad. Si las magnetozonas obtenidas en la magnetoestratigrafía local se pueden correlacionar de manera inequívoca con los crones de la ETPG se podrá asignar la edad absoluta a cada límite de magnetozona de la magnetoestratigrafía local y establecer un marco temporal preciso para secuencias sedimentarias o volcánicas.
¿Y todo esto para qué sirve? ¿Por qué queremos datar las rocas?
La magnetoestratigrafía es una subdisciplina mayor dentro del paleomagnetismo en la que estratígrafos y paleontólogos trabajan juntos para solucionar una gran variedad de problemas geocronológicos. La datación y el control temporal son esenciales en Ciencias de la Tierra, ya que nos permiten correlacionar a nivel global secuencias de rocas de localidades alejadas y de contextos geológicos muy distintos o calibrar el registro fósil con la escala de tiempo. Poder responder al CUÁNDO es muy importante para conocer la velocidad de determinados procesos geológicos y poder cuantificar los mecanismos responsables de nuestras observaciones.
Elisabet Beamud
Doctora en Geología.
Laboratorio de Paleomagnetismo CCiTUB-ICTJA, CSIC.
Es difícil que con 17 ó 18 años de edad, cuando llega el momento de decidir los estudios universitarios, uno se decante por un Grado en Química (u otro) sin ninguna incertidumbre. Lo más habitual es que se dude entre otros, como Bioquímica, Ingeniería Química, Física o Farmacia. Es normal y, además, uno puede terminar trabajando en tareas similares aunque parta de estudios diferentes, pues no siempre hay fronteras claras entre las áreas de conocimiento. Incluso, para ejercer de profesor de química y divulgador científico, que es lo que nos ocupa aquí, se puede llegar desde cualquiera de las titulaciones citadas… ¡y otras! A nivel personal, el autor de este texto eligió cursar la Licenciatura en Ciencias Químicas porque analizando planes de estudio de otras carreras de ciencias, le pareció la más generalista y con muy variadas especialidades.
Una vez que una persona obtiene el Grado en Química (o similar) existen distintas salidas profesionales, como se aborda en otros capítulos de este libro. Las oportunidades de trabajo son amplias, desde industrias del sector químico (síntesis de sustancias, fabricación de plásticos, fertilizantes, petroquímica…) y otras con implicaciones químicas (cementera, farmacéutica, pinturas, alimentación…), a plantas de tratamiento de agua, y muchas más (investigación, aduanas, restauración artística, etc.). Otra posibilidad laboral es el sector de la enseñanza, que ha venido ocupando a muchos profesionales de la química y, asociado a este ámbito, cada vez más, también nos encontramos con actividades de divulgación científica.
Aunque pueden existir otros tipos de "profesores de química", como de academias y profesores particulares, nos referimos aquí a los dos tipos más habituales: de enseñanza secundaria, formación profesional y bachillerato, y de Universidad. Para acceder al primer tipo, que se puede ejercer en centros privados, concertados o públicos, es necesario realizar un Máster Universitario en Formación de Profesorado. Dura un curso académico (60 créditos ECTS) y habilita para el ejercicio de la profesión regulada de Profesor/a de Enseñanza Secundaria Obligatoria y Bachillerato, Formación Profesional y Enseñanza de Idiomas. En él se abordan materias generales (psicopedagogía, procesos educativos, aprendizaje…), otras específicas (complementos de formación, didáctica de la especialidad, innovación docente…) y de aplicación (trabajo fin de Máster y prácticas educativas).
No existe en España una especialidad única de Química en el citado Máster, y lo más habitual es que esté englobada en una de "Física y Química" o análoga, como "Ciencias Experimentales". Suele ser así por tradición y, quizá lo más importante, porque en las modalidades de profesorado de educación secundaria, se engloban estas dos áreas. Esto ha sido, es, y será con seguridad, fuente de controversia. Por ejemplo, hay quien plantea que la química podría ir agrupada con la biología, y la física con las matemáticas, o incluso que hubiera, como en otros países, una separación mayor de áreas. La opinión del autor es que es difícil que se cambie. La práctica educativa española ha sido la del agrupamiento de dos áreas que no siempre conviven bien en un único campo. Hay alumnos que se lamentan de que no les explica bien la física un profesor de formación química, o viceversa, pero también es cierto que hay temas comunes (como la estructura y propiedades de la materia) y que si se subdividen surgirían otros problemas organizativos. Y todo esto no es solo propio de estas áreas; piénsese en "Geografía e Historia" o "Biología y Geología".
El profesor universitario de química requiere (por legislación) menos formación docente. De hecho, no se le exige ninguna preparación específica al respecto, porque su actividad va más asociada a una tarea investigadora. Salvo excepciones (como profesores asociados o al inicio de la carrera docente), el profesor de Universidad (en todas las áreas) es además investigador (también por legislación) y, por ello, para acceder a las distintas categorías profesionales, se exigen diferentes requisitos sobre ello (participación en proyectos, publicaciones, intervenciones en congresos, etc.). Existen agencias de evaluación universitaria autonómicas y una nacional (la ANECA, Agencia Nacional de Evaluación de la Calidad y Acreditación), donde los candidatos a ocupar plazas de profesor universitario se deben "acreditar" a las distintas figuras, que pueden ser de contratado (ayudante doctor, contratado doctor o de Universidad privada) o para los cuerpos de funcionarios (titular o catedrático). Una vez acreditados, los candidatos deben superar las pruebas establecidas en cada Universidad. Hay otras figuras, como ayudante o profesor asociado; para más detalles, se sugiere que se visiten las páginas Web de la ANECA (www.aneca.es) o las del propio Ministerio de Educación (que cada cuatro años lleva nuevas denominaciones adicionales; en la actualidad es, además, de Cultura y Deporte) para todo tipo de profesorado (http://bit.ly/2hqEkPJ).
No existe un tipo único de profesor universitario de Química; normalmente, aparte de la distinción entre Universidades públicas o privadas (en estas últimas suele primar más la labor docente frente a la investigadora), la mayor diferencia consiste en la impartición de materias específicas de química (Química Orgánica, Catálisis, Materiales…) o de química básica para distintos Grados (Biología, Farmacia, Ingeniería…). Este último es el ámbito del autor, que es profesor de Química, desde hace 32 años, en una Escuela que forma ingenieros (en concreto, industriales, químicos y de organización).
Aunque no se exige una formación docente, sí es considerada, en cierta medida, en los procesos de promoción y selección. Además, bien de forma autodidacta, bien a través de Institutos de Ciencias de la Educación de las Universidades y de congresos, los profesores universitarios suelen (o pueden) formarse en este ámbito.
En cuanto a labor investigadora, que es la que prima para el progreso profesional, el profesor universitario ha de llevar a cabo una tarea que se asemeja a la descrita en otros capítulos de este libro, por lo que no se trata de forma profusa. Sí hay que decir que no basta con "investigar"; cada vez más, y como se ha indicado, esa investigación "se mide". Por ejemplo, en su evaluación tiene mucha importancia la publicación de artículos en revistas de "índice de impacto" reconocido. Esto es así porque estas revistas someten los trabajos a la evaluación anónima por otros "pares" y, además, el citado índice mide la repercusión que tienen (por ejemplo en cuanto a citaciones) las publicaciones. Esto está cuestionado; hay profesores que se quejan de que han dedicado mucho tiempo a la docencia y por tener menos éxito en su investigación no pueden promocionar, mientras que hay investigadores que incluso llevan años en centros de gran prestigio internacional, que no encuentran posibilidad de acceder a plazas de profesorado por carecer de experiencia docente.
Como ocurre tantas veces, existen estereotipos. En concreto, el imaginario colectivo, parece que asocia al profesor de química como una persona excéntrica, alejada de la realidad y ensimismada en su mundo de humos y "brebajes", como se ilustra en la Fig. 1. En todo caso, encuestas recientes sobre apreciación de profesiones apuntan a que el profesorado universitario de ciencias, en general, es bien valorado por la sociedad, que reconoce las aportaciones científico-tecnológicas en el avance social.
Para mí, ha sido una suerte y un reto ejercer la tarea docente en un centro donde los alumnos quieren formarse como "ingenieros" y no siempre aprecian la "química" como una materia de interés para su formación.
Desde el principio, aparte de mi tarea investigadora (en espectroscopía aplicada y en el estudio de materiales compuestos de matriz polimérica) y de un desempeño "tradicional" de la docencia, he dedicado mucho tiempo a generar y poner en práctica nuevas herramientas educativas en las que se aplican los conceptos estudiados a resolver problemas de la vida cotidiana.

Fig. 1. Imágenes “tópicas” de profesores de química: en un anuncio publicitario (izda.) y en la popular película (The Nutty Professor) dirigida y protagonizada por Jerry Lewis en 1963. Se desea que los lectores de este capítulo aprecien estas imágenes con humor, pero alejadas de la realidad.
Buscando ejemplos de interés para motivar a mis alumnos, he descrito luego esos casos en revistas nacionales e internacionales [1], y los expongo habitualmente en congresos y cursos de formación del profesorado, dado que son aplicables en las diferentes etapas educativas. Es una de las tareas más enriquecedoras que he vivido como profesor, el intercambio de resultados con otros docentes en España y en otros países.
Para dar una idea de la variedad de los temas que he abordado en este sentido, se citan, a modo de ejemplo: hidratación de legumbres, cloración del agua, química de las sustancias antipolillas, analogías entre dimensiones de átomos y las de balones de distintos deportes, relaciones entre emisión de CO2 y consumo de combustible en automóviles, termoquímica de las bebidas autocalentables, aplicaciones prácticas del enfriamiento por evaporación, juguetes científicos, estequiometría de sustancias cotidianas (medicamentos, agua mineral, dentífricos…), efectos especiales en el cine, materiales "inteligentes", e importancia del uso de calderas de condensación. Todo esto forma un conjunto de propuestas metodológicas contextualizadas, muchas basadas en enfoques conocidos como ciencia-tecnología-sociedad. También he desarrollado propuestas educativas sobre relaciones entre ciencia, arte e historia, que creo que son importantes para la formación universitaria y en otras etapas educativas [1].

Fig. 2. El autor, explicando propiedades del “hielo seco” a jóvenes sorprendidos.
Por otra parte, en los últimos años ha habido un crecimiento exponencial del interés por la divulgación científica. Hoy en día existen multitud de programas de radio y televisión, blogs, páginas Web, revistas especializadas, etc. en torno a ello. También son frecuentes iniciativas curiosas, como una "pinta de ciencia" donde se divulga en cervecerías, o concursos de monólogos científicos, por citar otros ejemplos. Este interés se debe a varios motivos, como la necesidad de conocimiento de la población en general del fundamento de los logros propios de sociedades cada vez más tecnológicas, la relevancia de concienciar sobre la importancia de apoyo y financiación, y el interés por promover vocaciones científicas entre los más jóvenes.
De forma paralela a la enseñanza, hace años me di cuenta que buena parte de lo que trabajaba con mis alumnos, para "difundir" y explicar la química, también podría emplearse para su "divulgación" entre el público no especializado. En este sentido, he participado en multitud de ferias (entre las que destacaría los certámenes de Ciencia en Acción, http://cienciaenaccion.org/), encuentros, y jornadas de puertas abiertas en mi Universidad, destinado todo ello al público en general, y a los alumnos preuniversitarios en particular (ver Fig. 2). En todas estas actividades se aprecia cómo el ámbito de la divulgación encuentra analogías, pero también problemáticas y retos específicos, respecto del ámbito de la enseñanza.
Aunque buena parte de la divulgación científica es realizada actualmente por docentes, de forma altruista y como complemento a su labor educativa, constituye, cada vez más, una oportunidad profesional independiente, que encuentra salidas en los propios programas de radio y televisión aludidos, en museos, y en empresas de organización de eventos de divertimiento.
Por supuesto, la enseñanza, en su conjunto, es siempre gratificante. La mayor parte de mis alumnos "no adora" la química, pero son jóvenes con interés y con ilusión en su formación, y eso es lo importante. Como he intentado transmitir en este texto, me siento afortunado con mi profesión de profesor universitario y con las actividades divulgadoras que he llevado a cabo de forma paralela. Gracias a todo esto he desempeñado un empleo digno, he conocido a muchas personas (alumnos, profesores, participantes en eventos…), he visitado varios países, y he disfrutado "aprendiendo y enseñando" una ciencia que me parece apasionante y de vital importancia para la mejora de la sociedad. Y todo ello sustentado en una gran libertad de acción, que valoro profundamente. Creo que no se puede pedir más a una profesión. Por ello, siendo consciente de que "hay gustos para todo", animo desde aquí a jóvenes que dudan sobre qué rumbo seguir, dentro del mundo de la ciencia, a que no descarten la posibilidad de formar parte de la familia de profesores de química y divulgadores científicos.
Referencia:
[1] Recopilación de trabajos de didáctica y divulgación de las ciencias de G. Pinto: http://bit.ly/28KSGpA
Gabriel Pinto Cañón
Doctor en Ciencias Químicas por la Universidad Complutense de Madrid.
Catedrático de Universidad (área de Ingeniería Química) en la Universidad Politécnica de Madrid.
Aún recuerdo mis últimos días como estudiante de cuarto de ESO. Tenía que tomar una decisión: Bachillerato de Ciencias o de Sociales. Desde pequeña me ha encantado la literatura: leer, viajar a otros mundos, vivir otras vidas, soñar… Eso es, soñar. Eso es lo que me gustaba en realidad. Quizá por eso me decanté finalmente por el de Ciencias, porque sería como un sueño o como un reto para mí, que solía suspender Física y Química…
Un par de años más tarde llegó el segundo momento decisivo en la vida de cualquier bachiller: qué estudiar después. Desde pequeña había querido ser muchas cosas de mayor, desde patinadora artística (yo, que en mi vida he sabido patinar) hasta médico (yo, que me mareo cuando veo un poco de sangre). Vais comprendiendo lo que os comentaba antes acerca de soñar, ¿verdad? Afortunadamente tuve una profesora que marcó mi rumbo. Se llamaba Esther, como yo, y fue mi profesora de Física y Química durante mis cursos de Bachiller. Esther era química y le apasionaba enseñar. Fue ella la que me contagió las ganas de saber más, de no quedarme nunca en lo superficial de las cosas. Me contagió las ganas de aprender a pesar de las dificultades que eso conllevara. Así que, allí estaba yo un mes después de acabar 2º de Bachillerato…matriculándome en la Facultad de Ciencias Químicas de la Universidad Complutense de Madrid.
¿Qué hace un químico?
Si os estáis preguntando qué puede hacer un químico, creo que la mejor respuesta sería magia pues no podemos perder de vista que a los primeros químicos se les conocía como brujas, druidas, hechiceros…alquimistas. Personas que observaban y experimentaban porque esos son precisamente los principios básicos de cualquier científico. Pero no nos desviemos. Si quieres saber a qué puede dedicarse un químico no tienes más que mirar a tu alrededor y comprobarás que todo lo que te rodea es química, incluido tú mismo, por supuesto, pero te pondré algunos ejemplos y preguntas para que tú mismo realices algunas investigaciones:
-Industria alimenticia: detrás de todo lo que comes y bebes hay detrás un químico analizando que no te intoxiques mediante los llamados controles de calidad. ¿Sabías que la tónica es fluorescente?
-Industria textil: en esta rama los químicos aportan su granito de arena para contribuir en el desarrollo de nuevos tejidos o de mejora de los actuales, no solo para ir a la moda, también, por ejemplo, para facilitar que practiques deportes. ¿Sabes qué es el Neopreno®?
-Química forense: los químicos que se dedican a esta rama pueden analizar la composición de explosivos, determinar la presencia de drogas y venenos, investigar el origen de los incendios forestales, recogida y análisis de pruebas biológicas… ¿Te has preguntado alguna vez cómo se recogen las huellas dactilares?
-Industria cosmética y de perfumes: los químicos también se encargan de elaborar productos cosméticos así como de desarrollar técnicas de extracción de fragancias naturales de las plantas. ¿Sabes cuál es la diferencia entre los denominados eau de parfum, eau de toilette y colonia?
-Obras de arte: gracias a los químicos, se puede determinar la fecha de una obra de arte e incluso averiguar si es una obra original de un determinado autor o, por el contrario, una mera falsificación. ¿Sabrías decir un método para identificar obras de arte falsificadas?
-Docencia: hemos llegado al área a la que me dedico. Quizá sea el ejemplo que más has experimentado, pues todos hemos tenido profesores, pero ¿qué hace un profesor químico? Un profesor químico debe despertar la curiosidad por aquello que vemos y, sobre todo, por lo que no vemos. Debe ser capaz de despertar la curiosidad y dotar a sus alumnos de armas para no dejarse engañar, para cuestionar argumentos con los que se les pretenda convencer. Debe dar alas al conocimiento y a la imaginación para que sean libres de llegar hasta donde ellos quieran porque, con la ciencia a tu lado puedes recorrer los caminos que tú quieras. No le tengas miedo aunque a veces te lleve a algunos baches. Nadie dijo que fuera fácil pero te aseguro que el camino científico merece la pena.
Podría ponerte muchos ejemplos más de actividades que puede llevar a cabo un químico pero estoy segura de que te has podido hacer una idea de su amplitud.
¿La química tiene futuro o ya está todo conseguido?
Es posible que pensemos que ya está todo descubierto o que no podemos aportar nada nuevo a todo lo que ya sabemos. Pues bien, si piensas así estás muy equivocado. La ciencia en general y la química en particular, no tiene límites. Hoy en día hay muchas líneas de investigación abiertas, no tienes más que curiosear el sitio web de cualquier universidad para encontrar apartados dedicados a explicar las investigaciones en curso.
Hay de todo tipo: nuevos fármacos, nuevas baterías, nuevas técnicas de análisis, nuevos materiales más resistentes o útiles para determinadas actividades, nuevas técnicas para eliminar residuos en el agua, etc. Como ves, el abanico es muy extenso y en la mayoría de ellos no solo trabajan químicos, también personas de otras áreas como físicos, biólogos, médicos… Es importante compartir conocimientos y saber colaborar con personas que saben de lo que nosotros no sabemos. Juntos llegamos más lejos.

Fig. 1. Teoría de Orbitales Híbridos. No podéis imaginar la alegría que sentí cuando tuve que explicar esta teoría por primera vez y conseguí que mis alumnos la comprendieran. Y no solo eso, también conseguí, a través de esta explicación, comprenderla yo plenamente, cosa que no había conseguido hasta entonces.
No imaginas la cantidad de personas y culturas que puedes llegar a conocer siendo científico.
Como conclusión…
…te diría que merece la pena apostar por la ciencia y que eso no significa que dejes de lado otras disciplinas que te gusten. Yo sigo siendo una apasionada de la literatura, especialmente de aquella que no tiene que ver con divulgación científica. Me gustan las novelas de misterio y de las que te llevan a ciudades que no conoces. Es importante saber desconectar también. Te diría también que tengas la mente muy abierta, no seas cabezota y te cierres a que tus ideas y tu concepción del mundo son las correctas. Puede que tengas razón, pero puede que esa razón desaparezca con el descubrimiento de alguien.
Tienes a toda la comunidad científica de tu lado, anímate a formar parte de ella.
¡Anímate a descubrir!
Esther Escobar Rivera
Graduada en Ciencias Químicas por la Universidad Complutense de Madrid.
Profesora de Ciencias y miembro de la Real Sociedad de Química en el grupo de Didáctica e Historia de la Física y la Química.
¡Me encanta la Química!; me quedo con la boca abierta cuando mi profe hace experimentos en clase y nos dice que Química es todo lo que nos rodea.

Fig. 1. Químico malo visto por algunos.
Cuando le digo a mis amigos que quiero ser química, algunos me preguntan que eso para qué sirve, que si tiene futuro, que si hay trabajo…Otros ponen una cara horrorosa y me cuentan que los químicos destruyen el mundo, que fabrican bombas, que sintetizan drogas (Fig. 1). Me preguntan si quiero ser como el protagonista de la serie Breaking Bad, un frustrado profesor de Química de un instituto que cuando le diagnostican un cáncer terminal contacta con un antiguo alumno suyo para fabricar y vender metanfetamina (un potente psicoestimulante) y de ese modo asegurarle el bienestar económico de su familia cuando él muera. Hay otros que me dicen, que ellos sólo consumen productos "libres de químicos"…, porque para ellos la palabra químico es sinónimo de toxinas o de veneno.

Fig. 2. Mi profesora de Química.
Pero yo creo en lo que dice mi profe (Fig. 2), que la química no es ni buena ni mala, y que, como todo, depende del uso que hagamos de ella. Así que un día nos dijo que íbamos a preparar una "bomba de vitaminas" y vino a clase cargada de naranjas y un exprimidor. Le echamos una mano a exprimir naranjas y nos sentamos en el patio a disfrutar de nuestro "almuerzo natural supuestamente libre de químicos", como nos dijo. Pero de vuelta a clase, nos dibujó en la pizarra una fórmula llena de átomos de carbono (C), hidrógeno (H) y oxígeno(O) y una letra seguida de un número (Fig.3).

Fig. 3. Ácido ascórbico, presente en el zumo de naranja.
Nos dijo que esa molécula química se llama ácido ascórbico y que está presente en el zumo de naranja natural que acabábamos de bebernos. Además, el ácido ascórbico está catalogado como E300, que lejos de ser un malvado aditivo, no es sino vitamina C. Precisamente la falta de vitamina C produce una enfermedad conocida como escorbuto, muy común entre los marineros que realizaban largas travesías durante la Edad Media y la Edad Moderna, ya que entonces la obtención de frutas y verduras era muy complicada. Así que, si vemos escrito E300 en la etiqueta de un producto alimenticio, no tenemos que asustarnos.
Aquellos que desarrollan un odio irracional a cualquier producto químico, conocido como quimiofobia, deberían saber que absolutamente todo está compuesto por átomos y moléculas por lo que, como dice mi profe, todo es química. Por ejemplo, cuando echamos vinagre a una ensalada, estamos rociándola con ácido acético, también llamado ácido metilcarboxílico o ácido etanoico (C2H4O2), el queso no sale de la vaca tal cual, sino que sufre un proceso químico llamado fermentación, la sal no es otra cosa que cloruro sódico (NaCl) y el azúcar común es sacarosa (C12H22O11).Por tanto, no podemos hablar de natural o químico, sino de productos químicos naturales y de productos químicos artificiales (o sintéticos).

Fig. 4. Bebé con metahemoglobinemia [1].
Mi profe nos contó otro día en clase que la población mundial está creciendo de manera exponencial y que cada vez hay mayor demanda de alimentos, de medicamentos, de agua, de ropa, de combustibles…. Muchos de esos recursos son limitados, los combustibles fósiles se están agotando, en muchos países no hay agua potable y mucha de la ropa que llevamos puesta se fabrica en países donde las condiciones de trabajo no son las adecuadas. Además, el hombre cada vez genera más desechos y éstos necesitan ser tratados antes de arrojarlos al suelo, al aire o al agua. Dice que los químicos podemos hacer mucho por mejorar las condiciones de vida en países subdesarrollados. Entonces nos enseñó una foto de un bebé azul (Fig. 4). Tenía una enfermedad llamada metahemoglobinemia, conocida también como "síndrome del bebé azul". Se trata de un trastorno de la sangre que, aunque puede ser congénito, también es causado por la exposición a unas toxinas, los nitratos y nitritos, que se encuentran en gran cantidad en acuíferos contaminados debido al uso excesivo de fertilizantes y a los desechos de aditivos alimentarios. Los nitratos y nitritos afectan a la hemoglobina, una hemoproteína de la sangre, que contiene hierro y le da su color rojo característico. La hemoglobina es la encargada de transportar el oxígeno (O2) desde los órganos respiratorios hasta los tejidos. La mayor parte del oxígeno que respiramos se utiliza para obtener energía a partir de los nutrientes mediante el metabolismo. Por ello, la falta de oxígeno es letal, impide la generación de la energía necesaria para mantener vivos nuestros tejidos. El oxígeno que llega a los pulmones se une al hierro de la hemoglobina y lo transporta a través de la sangre hasta las células de los tejidos, donde se libera. Se necesita, por tanto, que la hemoglobina sea capaz tanto de captar como de ceder oxígeno y eso se consigue gracias a que contiene hierro en un estado de oxidación relativamente bajo (Fe2+). Sin embargo, los nitratos y nitritos del agua contaminada oxidan el hierro de la hemoglobina y lo transforman en Fe3+. Este hierro oxidado tiene muchísima más afinidad por el oxígeno, de modo que la hemoglobina que contiene Fe3+, llamada metahemoglobina, puede transportar el oxígeno por la sangre pero no es capaz de cederlo a los tejidos. Esto causa cianosis, que es la coloración azul de la piel. Como los bebés tienen muy bajo peso, y su organismo carece de enzimas capaces de reducir de nuevo el Fe3+ a Fe2+, son especialmente propensos a esta enfermedad, que puede causarles la muerte. Me dio mucha pena ver ese bebé azul…

Fig. 5. Contaminación del río Tullahan entre Caloocan y Valenzuela (Filipinas) [3].
Pero mi profe nos ha dicho que en la universidad hay un grupo de químicas y químicos que están investigando unos materiales poliméricos especiales que conducen la electricidad y que son capaces de reducir a los nitratos (NO3-) y nitritos (NO2-) del agua y convertirlos en nitrógeno, ese mismo nitrógeno (N2) que está en el aire, y que por tanto es benigno [2].
Mi profe también nos cuenta que en los países desarrollados tenemos mucha suerte de disponer de plantas potabilizadoras de agua y de leyes que regulan el vertido de los desechos industriales. Pero en los países subdesarrollados o en vías de desarrollo, eso no es así. Un día nos enseñó una foto del río Tullahan entre Caloocan y Valenzuela, en Filipinas [3]. El agua del río está llena de una espuma teñida por los colorantes que se vierten procedentes de fábricas de papel y textil que se encuentran río arriba. Mi profe nos dijo que los químicos de la universidad están utilizando unos fotocatalizadores basados en dióxido de titanio que aceleran las reacciones de degradación de contaminantes orgánicos, disolventes, pesticidas y colorantes, que son difíciles de descomponer por otros métodos. La energía necesaria la obtienen de una fuente limpia y abundante, el sol.

Fig. 6. (a) y (b) Degradación de la rodamina G con luz solar; (c) Espectrofotómetro UV-vis.
Además, para aprovechar no sólo la radiación más energética, pero a la vez menos abundante del sol, que es la radiación ultravioleta, están dopando esos fotocatalizadores de modo que aprovechen todo el espectro visible del sol. Con su método consiguen destruir las sustancias tóxicas del agua y convertirlas en compuestos totalmente inocuos, como agua (H2O) y dióxido de carbono (CO2). Así que un día nos llevó a visitar los laboratorios de química de la universidad, y allí nos enseñaron unos tubos de ensayo en los que habían introducido agua y colorantes (rodamina G y azul de metileno) y vimos cómo, en presencia de esos materiales híbridos dióxido de titanio/polímero conductor que habían sintetizado [4], el color que teñía el agua desaparecía conforme se degradaba el colorante expuesto al sol (Fig. 6). Todo esto lo analizaban con un espectrómetro ultravioleta-visible, y además tenían un microscopio electrónico con el que podían ver la microestructura de los materiales capaces de limpiar el agua.
En la universidad también nos contaron que antes, en las fábricas de calzado aquí en España, se utilizaban tratamientos químicos y colas para los zapatos con disolventes orgánicos muy perjudiciales como el n-hexano, que producían en los trabajadores una enfermedad llamada "parálisis del calzado" [5] porque afectaba al sistema neurológico produciendo parálisis en piernas y brazos. Las fábricas no tenían ventilación forzada o campanas de extracción como en los laboratorios de la universidad. Pero gracias al desarrollo de tratamientos alternativos para las suelas de zapatos, que en lugar de disolventes nocivos, emplean radiaciones semejantes a las que generan ozono en una tormenta eléctrica [6], y también gracias al desarrollo de adhesivos en base acuosa, se ha mejorado la salud de los trabajadores. Y todo ello se ha conseguido gracias a la investigación de químicos y químicas que se preocupan por la salud y el medio ambiente.
Sin embargo, el desarrollo de la Química no es suficiente para solucionar todos los problemas de contaminación, salud laboral, superpoblación, falta de recursos, búsqueda de nuevos combustibles, tratamiento de desechos industriales…..Es necesario que nuestros dirigentes trabajen e inviertan en políticas que mejoren la calidad de vida, que frenen el calentamiento global y la desertización, que inviertan en investigación. Y para poder reclamar todo esto como ciudadanos concienciados, hace falta saber mucha química….
Así que, YO QUIERO SER QUÍMICA, porque quiero aportar mi granito de arena y hacer del nuestro un mundo mejor.
Referencias:
[1] Youtube
[2] M.Jesús García-Fernández, R. Buitrago-Sierra, M. M. Pastor-Blas, A. Sepúlveda Escribano. "Plasma-assisted preparation of polypyrrole-supported catalysts. Application to nitrate removal in water" en Recent Advances within the field of Materials Science in Spain" (2015). Secretariado de publicaciones. Universidad de Alicante. ISBN:978-84-9717-346-9.
[3] Greenpeace
[4] Víctor Belda Alcázar, "Síntesis y caracterización de materiales híbridos titania/polianilina y titania/polipirrol para la fotodegradación de rodamina 6G y la eliminación de nitrato del agua", Trabajo de Fin de máster tutorizado por M.M. Pastor Blas. Junio 2015.
[5] porexperiencia
[6] M. Mercedes Pastor-Blas. "Los tratamientos superficiales de materiales de caucho en la industria del calzado". Red Temática VIII.D. CYTED. J.M. Martín-Martínez, Teresa del Pilar Ferrándiz Gómez (Eds.). Universidad de Alicante, VIATECNIA (2000). ISBN: 84-607-0689-3
Mª Mercedes Pastor Blas
Doctora en Química, Catedrática de Universidad.
Laboratorio de Materiales Avanzados, Departamento de Química Inorgánica e Instituto Universitario de Materiales, Universidad de Alicante.
Yo de pequeña soñaba con ser bailarina, después quise ser astronauta, más adelante decidí que quería dedicarme a la odontología y a día de hoy me he convertido en química médica. Como podéis ver cambié de opinión sobre mi futuro varias veces a medida que iba descubriendo mundo y ciencia. Pero por muchos cambios, me atrevo a afirmar que, si volviera a nacer, volvería a dedicarme a la química.

Cuando era pequeña tenía una curiosidad infinita y una necesidad, a veces un tanto angustiosa, de saber el porqué de las cosas.
Recuerdo una carta de reyes donde pedía un microscopio para poder buscar los pulmones de las plantas porque bien tienen que respirar si son seres vivos. Años más tarde, la ciencia me enseño que las plantas respiran a través de sus hojas captando el oxígeno del aire. Cuando preparábamos la cena los lunes me preguntaba porque las claras de los huevos se volvían blancas cuando se calentaban. Hoy sé que las proteínas de la clara del huevo se desnaturalizan cuando aumenta la temperatura, y por ello cambian su aspecto. Cuando era pequeña me preguntaba por qué el agua del mar era azul pero el agua que salía de la ducha no. Hoy sé que el agua es incolora, y el color del agua del mar se debe al reflejo del cielo en el mar.
Para esa época todavía no tenía muy clara la diferencia entre las distintas disciplinas científicas; pero lo que nunca dudé es que ciencia era lo que quería hacer en mi vida. Porque la ciencia tiene respuestas y una explicación para todo, y eso, es fascinante.
Empecé bachillerato, y conocí al profesor que hizo decantar la balanza hacía la química. Él me enseño la química de la forma más sencilla, cotidiana y divertida que jamás haya podido imaginar, el estudio y el aprendizaje se convirtieron en un juego el cual nunca he dejado (ni quiero dejar) de jugar. Gracias a él aprendí que con la química no existe frontera de lo imposible y que el único límite lo pone tu imaginación. Recuerdo que él siempre nos decía "¡Todo se puede explicar con la química!"
Y no se equivocaba, las plantas respiran por la difusión del oxígeno, las proteínas pierden su estructura cuando reciben energía, la interacción luz – materia explica los colores de las cosas. Cuando juntamos unos cuantos átomos en una forma determinada obtenemos un fármaco que nos alivia el dolor; si hacemos colisionar dos átomos obtenemos energía nuclear; cuando comemos nuestro organismo rompe la comida en partes más pequeñas que nos proporcionan energía y vitaminas; si nos queremos tirar a la piscina, el cerebro, mediante una señalización química avisa a nuestras piernas para que salten… ¡Fascinante!
Decidir estudiar química, creo que fue una de las mayores y mejores decisiones que he tomado en la vida. Me divierto haciendo ciencia, al tiempo que aprendo y además contribuyo a mejorar la calidad de vida de las personas.
La segunda decisión importante que tomé, fue cuando decidí que quería curar el cáncer. Esta tampoco fue una decisión tomada en un minuto, sino que su reflexión me llevo alguna que otra tarde; aunque recuerdo perfectamente el momento que vi la luz.
Me encontraba en el último año de mis estudios universitarios, todo eran dudas, indecisiones, un futuro por delante, todas las opciones posibles encima de la mesa y tocaba tomar otra decisión importante. Era momento de focalizar mis estudios, escoger un área de estudios, decidir, en pocas palabras, cómo o qué quería ser al cabo de 5 años.
Era una tarde de primavera, estaba tomado un café con una amiga y compañera de universidad y hacía meses que ese era nuestro tema de moda: ¿Y ahora qué? Y mientras hablábamos, yo iba reflexionando: quería un gran reto personal y profesional, que marcará un antes y un después en mi mundo y en el mundo científico (siempre me ha gustado pensar a lo grande); pero a la vez quería ayudar a la gente, mejorar sus vidas. Y las opciones se iban reduciendo… Prefería una bata de laboratorio antes que un traje y una oficina, prefería experimentar y divertirme probando nuevas cosas antes que seguir una rutina, y claro, quería hacer algo grande, un gran reto. Y de repente, lo vi todo claro: el cáncer, había que erradicar el cáncer.
Y así fue como decidí que de mayor quería ser química médica. Química, evidentemente, mi mundo gira en torno a dicha ciencia y médica porque, aun sin saber de medicina, trabajo en un tema médico como es la enfermedad del cáncer. Pero yo no me dedico a tratar pacientes, yo me dedico a intentar entender cómo viven y sobreviven las células de cáncer y encontrar un mecanismo o tratamiento que sea más fuerte que ellas.
Es completamente fascinante, cultivo unas células de pacientes extraídas con una biopsia del tumor, les doy de comer, las mantengo a una temperatura agradable para ellas y hago que crezcan millones y millones. Después les añado un biomaterial que solidifica y se forman unos micro-tumores de cáncer en el laboratorio. Es completamente fascinante. A los tumores les doy de comer y crecen, se hacen más grandes y aparecen más células. Y en este momento, empiezo a hacer volar la imaginación y a jugar. Y nunca se me olvida que "la química no tiene frontera en lo imposible"
Me dedico a entender el cáncer desde un punto de vista celular, cómo se organizan las células, sus mecanismos de resistencia a los fármacos, cómo se reproducen y cómo una sola célula es capaz de liberarse del tumor y anclarse a otra parte del cuerpo para hacer crecer otro. Para ello, imaginación: les cambio la temperatura, les inyecto fármacos, productos tóxicos, nanopartículas, les limito el oxígeno que tienen para respirar, las irradio con luz… y podría escribir páginas y páginas, y vosotros también podríais, de todas y cada una de las ideas para hacerle "la vida" más complicada a las células de cáncer. Es completamente fascinante.
Porque después de todo, ellas siguen vivas y siguen reproduciéndose. Y eso es lo más fascinante de todo y uno de los retos más duros que he vivido nunca. En la selva, los animales sobreviven por la "ley del más fuerte"; cuando se trata del cáncer, sobrevive el más hábil y perspicaz. A día de hoy no lo somos los científicos, pero con más conocimiento y más juegos, algún día le vamos a ganar la batalla.
El cáncer, y encontrar su cura o un tratamiento eficaz es uno de los retos más impresionantes que tiene la comunidad científica a día de hoy. No es el único, pero para mí es el más sorprendente y formar parte de ello me genera una gran ilusión.

Fig. 1. Células cancerígenas (PANC-1) y fibroblastos humanos (hNDF) con una tinción DAPI (azúl: núcleo, rojo: citoesqueleto), visto con un microscopio.
Pero no termina aquí, cada día aparecen nuevos retos científicos y los químicos somos una parte muy importante en la búsqueda de soluciones.
Una vez te conviertes en químico, no hay nada que se te resista, y no lo olvides: ¡Con la química desaparece la frontera de lo imposible!
Júlia Dulsat Mas
Graduada en Química con un Máster en Química Farmacéutica
PhD candidate en el Departamento de Bioingeniería en la facultad IQS-SchoolofEngineering, Universidad Ramon Llull (Barcelona)
Aún recuerdo los rostros de varios premios Nobel que se reunieron en el Puerto de la Cruz (Tenerife) en 1980 en el denominado 12th International Symposium on the Chemistry of Natural Products que organizó la Universidad de La Laguna (ULL) en nombre de la IUPAC [1].

Fig. 1. (+)-mentol
Entre ellos destacaba el profesor Barton [2], un inglés de cara rojiza y pelo frito del que todo el mundo hablaba por tenerlo por una eminencia de la química orgánica, y es que en 1969, Barton había sido galardonado con el premio Nobel en Química, compartido con Odd Hassel «por sus contribuciones al desarrollo del concepto de conformación y sus aplicaciones en química». Obsérvese en la Fig. 1 lo que hoy entendemos por "conformación del mentol". Ocho licenciados, recientemente especializados en química orgánica por la mencionada ULL, allí asistíamos escuchando a sus eminencias discursos relacionados con el bio-petróleo, síntesis de sustancias bioactivas demandadas por la industria farmacéutica, espectroscopía, etc. El eminente y viejo profesor D. Antonio González González [3], organizador del evento, se esforzaba por que todo saliese bien. Entre tanto trajín, sin embargo, encontró tiempo para sentarse conmigo, y me dijo: ¿ves a estos? - señalando para los premios Nobel y demás genios que discutían complejas fórmulas químicas que escribían sobre el papel mientras fumaban con sus cachimbas-, pues que sepas que para llegar a su nivel "solo tienes que trabajar". Tras treinta y siete años de aquel evento, he trabajado en química orgánica como el que más, y aún no he sido galardonado con el Nobel, pero sí creo que he aportado datos nuevos que importantes revistas relacionadas con la química orgánica han tenido a bien publicar [4]. Dichos datos sirven hoy de inspiración a las nuevas generaciones de estudiantes y, quizá algún día, sean la llave para que alguien descubra algo relevante. Al igual que, para que una catedral se acabe de construir, alguien tuvo que poner la primera piedra, del mismo modo, la construcción del edificio del bioconocimiento requiere humildes obreros especialistas en química orgánica.
¿Qué es la materia orgánica, qué es la química orgánica y para qué sirve?
Toda ciencia se caracteriza por un objeto de estudio y un método de estudio. El objeto de estudio de la química orgánica es la materia orgánica, la cual se puede definir como la sustancia principal de la que están hechos los organismos. El elemento estrella que la constituye es el carbono, pero también encontramos en sus estructuras moleculares otros átomos (H, O, N, P, S, Cl, Br, etc.). Se formó -y se sigue formando- a través de complejas rutas biogenéticas que se enraízan en la fotosíntesis, ya presente en los primeros microorganismos fotosintéticos. Puestos a clasificarla por estructura, diferenciamos nombres como azúcares, ácidos grasos, aminoácidos, terpenos, fenoles, polisacáridos, lípidos, proteínas, etc. Estos materiales, tras cumplir su papel en el fenómeno que denominamos "vida", se acumulan en el medio ambiente y juegan un rol en el movimiento de nutrientes y en la retención del agua en la superficie del planeta.
En cuanto al método de estudio, lo definiríamos como un conjunto de dogmas (como "la valencia del carbono es siempre cuatro") y técnicas (como la "cromatografía en capa fina" o la "resonancia magnética nuclear") que nos permiten llegar a describir la estructura tridimensional de las moléculas que constituyen un sólido, un líquido o un gas, con la profundidad de su estructura conformacional privilegiada en condiciones particulares de pH, temperatura, disolvente, etc.

Fig. 2. Estructuras del halimedatrial (arriba) y del eritrolido (abajo).
Así, en la actualidad decimos que la Fig. 2 describe las estructuras moleculares del halimedatrial y del eritrolido. El primero es un compuesto sólido que biosintetizan y bioacumulan las algas marinas del género Halimeda para defenderse de los peces que las depredan, y el segundo es otro sólido que fabrican los corales blandos del género Erythropodium con el mismo objetivo. Se trata, pues, de sustancias biológicamente activas fagorrepelentes y, por tanto, son alomonas [5]. Así, pues, los seres vivos son productores de compuestos con estructuras más o menos complejas, que tienen una función ecológica/ fisiológica. Esto influye y determina aspectos tan importantes como los paisajes terrestres y marinos que observamos cuando salimos al campo o buceamos. Pero esto, ¿sirve para más? Veamos, si una vistosa esponja marina como Aplysinaaerophoba aprendió a biosintetizar y bioacumular productos químicos que la protegen de la oviposición de organismos extraños –erizos, crustáceos, etc.-, esto es, productos químicos que matan los huevos y las larvas de dichos animales competidores, ¿acaso no es lógico, por extrapolación, que dichos productos químicos también van a ser tóxicos para las células malignas que provocan enfermedades como leucemia o cáncer? Ciertamente, dicho organismo se defiende con productos químicos como la verongiamida (Fig. 3), tanto de los peces carnívoros de su hábitat como de los mencionados huevos y larvas de organismos extraños. No es de extrañar que dicha sustancia presente actividad inhibidora de las líneas celulares de leucemia humana [6]. En concreto, presentó actividad citotóxica frente a la línea celular HL60, matando el 50% de las células a una concentración de 10 μmoles por litro. Por otra parte, este compuesto también presenta citotoxicidad frente a líneas celulares de diferentes tumores, como el Ehrlichascitestumour (EAT) o el HeLatumour [6].Todo ello convierte a este producto natural marino en un potencial fármaco para el futuro. No es de extrañar que nuestro grupo de investigación ya esté trabajando en el campo de la maricultura de la esponja marina en mar abierto dentro del proyecto tractor de Desarrollo Industrial Sostenible de Canarias (DISCan-2007) [6]. El lector desconfiado se estará preguntando ¿es esto realista?, ¿en el futuro vamos a obtener fármacos por cultivo intensivo de esponjas marinas?
Dicen que para muestra, con un botón basta, pues bien, mostremos el caso del taxol (paclitaxel). Este es un fármaco que se viene utilizando desde hace tiempo en la quimioterapia del cáncer de pulmón, ovario, mama y otros. Es un compuesto que biosintetiza un árbol, el tejo del Pacífico, Taxusbrevifolia. Sin embargo, un tejo de 13 metros de altura y con 200 años de edad solo puede proporcionarnos medio gramo de taxol, por lo que los químicos orgánicos diseñaron un método sintético para convertir en taxolla 10-deacetilbaccatina, un compuesto relacionado desde el punto de vista estructural que se encuentra en varias especies no amenazadas del tipo del tejo del Pacífico y que puede ser cultivado sin destruir el árbol, esto es, de forma sostenible [7].
Para muchas otras cosas sirve la química orgánica. Así, algunos laboratorios se esfuerzan por sintetizar drogas complejas, como la morfina, que conserven sus propiedades útiles (la analgesia) pero no las indeseables (adicción).

Fig. 3. Verongiamida (también denominada dienona por su estructura molecular). Es un producto de alto valor añadido por su actividad biológica. Es presumible que en el futuro se cotizará en el mercado del sector biomédico y ayude a salvar vidas o a mejorar la calidad de vida de animales y hombres. Es un producto para la moderna “economía azul”.
Los estereoisómeros, ordenamientos tridimensionales diferentes con la misma fórmula molecular, pueden tener efectos terapéuticos muy diferentes. Un caso es el par quinina/ quinidina. El primero sirve para tratar la malaria mientras que el segundo se aplica para tratar arritmias cardiacas. Por otra parte, disciplinas cercanas, como la bioquímica o la nutraceutica, utilizan el "lenguaje" de la química orgánica para justificar, basándose en la estructura de las biomoléculas, su comportamiento. Así, entendemos que la estructura de doble hélice del DNA se forma gracias a los enlaces de hidrógeno entre las bases. También razonamos, basados en que la mayoría de las vitaminas tienen átomos con carga, el que sean hidrosolubles, o sea, el que se eliminen fácilmente y no sean tóxicas. Sin embargo, las vitaminas A y D, por ser no polares, se acumulan en el tejido graso del cuerpo, lo que las hace potencialmente tóxicas en altas dosis.
¿Y cómo podemos ver la estructura de la materia orgánica? ¿Hay instrumentos que nos permiten elucidar incluso la organización tridimensional de las moléculas?
Las moléculas que constituyen la materia orgánica solo se pueden "ver" por su manera de interaccionar con la radiación electromagnética en sofisticados instrumentos (espectrofotómetros) o su manera de romperse en un espectrómetro de masas. Dicha interacción se suele representar en forma de gráfico - espectro. La información contenida en dicho espectro permite deducir grupos estructurales típicos. Así, en la Fig. 4 puede observarse un espectro de resonancia magnética nuclear (1H-RMN) que corresponde a un líquido comercial, el metilimidazol. La posición relativa de los picos sobre el espectro, su intensidad y forma desvelan tres hidrógenos en una subestructura de imidazol. La información contenida en otros espectros debe de ser consistente con la estructura deducida, al igual que las diferentes piezas de un puzle deben de encajar en el mismo. Solo cuando esto ocurre, el químico orgánico se atreve a proclamar la estructura química en una publicación científica.
A modo de conclusión
La química orgánica es una de las partes de la química más necesarias para interpretar y desarrollar el mundo actual. Tanto el análisis cualitativo, cuantitativo y estructural de los componentes orgánicos que constituyen la materia como su síntesis configura una actividad científica que se desarrollada vertiginosamente en la actualidad.

Fig. 4. Espectro de 1H-RMN del metilimidazol (protones aromáticos) obtenido en la Universidad de Las Palmas de Gran Canaria.
El sector económico que más dinero mueve en nuestra sociedad, el denominado "Calidad de Vida de los Ciudadanos", necesita tanto de fármacos, cosméticos y nutracéuticos como de biodiesel y bioproductos, los cuales, es presumible que nos ayudarán a construir un mundo más limpio, saludable y sostenible. Muchos retos, como el descubrir esa molécula que acabe definitivamente con el Cáncer siguen abiertos e inspiran nuestro trabajo cotidiano. ¡Súmate!
Referencias:
[1] Web de la IUPAC.
[5] Francisco Javier Toledo Marante (2017). Marine EnvironmentalMetabolomics. In: Prasain JK (Ed.) Metabolomics, Fundamentals and Applications. Intech, USA.
[6] Pere Ferriol, Francisco J. Toledo, Miquel Brunet, María J. Mediavilla, Francisco J. Estévez, Christian C. Toledo (2013). Production of sponge cytotoxic factors by mariculture of Verongiaaerophoba. XIV International Symposiumon Marine Natural Products (MaNaPro-2013). Isla de La Toja - Galicia, España Póster 178. Pág. 243.
Francisco Javier Toledo Marante
Doctor en Ciencias Químicas –Especialidad Química Orgánica-.
Profesor Titular, Instituto Universitario de Medio Ambiente y Recursos Naturales (IUNAT) Universidad de Las Palmas de Gran Canaria (ULPGC)
Capítulo 53
Y yo quiero ser...Químico y Trabajar en la Industria Química
(Por José Antonio Martínez Pons)
Y yo quiero ser...Químico y Trabajar en la Industria Química
(Por José Antonio Martínez Pons)
Un poco de historia
Intentar definir la química no es fácil. Incluso su nombre es misterioso, por ejemplo, hay quien piensa que "química" deriva de "khemeia" que a su vez deriva de "Kham", nombre antiguo de Egipto. Por tanto, la química sería el "arte de los egipcios". También podría significar "arte negro" en el sentido de arte oculto ya que los "químicos" guardaban secreto sobre sus artes. Otros sin embargo creen "khemeia" deriva del griego "khumos", jugo, por tanto, la química sería el "arte de extraer jugos". Ninguna de estas definiciones es del todo exacta. Realmente como ciencia en el sentido moderno, la química es una ciencia joven, pero el ser humano hizo química, sin saberlo desde los albores de la civilización, por ejemplo, cuando descubrió y utilizó los efectos que producía el fuego sobre muchos objetos como cocer la comida o convertir el barro en cerámica. También descubrió los tintes y las pinturas y hace uno milenios aprendió a dominar y a obtener los metales. Tanto es así que en muchas partes del mundo los forjadores eran sagrados y tenían paso libre en todas las fronteras. Era obvio que el pueblo que contaba con los mejores herreros tenía las mejores herramientas y las mejores armas. La Biblia narra que los filisteos, muy posiblemente griegos, dominaron a los israelitas hasta que Saúl fue capaz de conseguir armas de hierro y se pudo enfrentar a ellos en igualdad de condiciones. Resumiendo, desde los albores de la cultura el ser humano ha hecho química sin saber que la hacía.
Alquimia, alquimistas y otros personajes
La primera "química" fue lo que conocemos por alquimia. Realmente el alquimista no indagaba en el porqué ocurrían los fenómenos que estudiaba, el buscaba por un lado obtener el medio de convertir metales "corrientes" en oro y por otro encontrar algo, el elixir de la vida, que le garantizara la salud. Naturalmente en este camino envuelto en misterios (arte hermético) y solo para iniciados descubrió técnicas y sustancias químicas muy interesantes, pero este no era su objetivo final sino un camino hacia la gran obra. Los alquimistas chinos descubrieron la pólvora buscando la panacea ideal, y en occidente la invención de esta mezcla se atribuye al mítico monje alemán Bertold Schwartz. Otros o ellos mismos buscaban medicinas destilando y volviendo a destilar, es una etapa de la química llamada iatro química.
Los alquimistas no se consideraban "científicos" sino "artistas". Sus ideas básicas eran muy simples, aceptaba ya fuera la teoría griega de los cuatro elementos (aire agua tierra y fuego) y las cuatro cualidades (frio, caliente, seco y húmedo), o bien la del mercurio, azufre y sal, como constitutivos de la materia. Aceptaban siete metales que asociaban a los "siete" planetas. Cuando se fueron descubriendo nuevos metales no hubo problemas los nuevos metales se consideraban variedades de los existentes del mismo modo que "existen distintas variedades de manzanas". Pensaban que los metales se "criaban" como los árboles, partían de una semilla que había que regar con el elixir adecuado. La transmutación por supuesto era posible.
¿Cómo permanecen ciertas ideas?
Estas ideas perduraron por más de mil años. Se puede decir que la química actual nació a finales del siglo XVIII y principios del XIX, cuando Lavoisier, Dalton, Proust y Richter establecieron las cuatro leyes ponderales de la química y Dalton propuso el modelo atómico molecular de la materia.

Fig. 1. Los cuatro elementos griegos y sus símbolos. Aristóteles añadió la quinta esencia.
Por ejemplo todavía en 1637 se publicó el libro "El arte de los metales" escrito por el Licenciado Álvaro Alonso Barba, natural de Lepe y sacerdote en la parroquia de San Bernardo en La imperial Potosí,(hoy en Bolivia).
Donde describe todo lo que se sabía sobre mineralogía y metalurgia de su tiempo, incluidos los métodos extracción de los metales preciosos sobre todo la plata, sin embargo, don Álvaro era creyente en las teoría de los cuatro elementos y en la transmutación de los metales, es decir que con bases teóricas erróneas, consiguió procesos efectivos y prácticos es de destacar su método de los "cajones" para purificar plata.
Entre otras "pruebas" propone que si se sumerge una lámina de hierro en una disolución de caparrosa azul (Fig. 3) el hierro se convierte en "cobre fino" En la figura se aprecia la disolución de caparrosa (sulfato de cobre) y una disolución análoga en la que se introdujo un clavo, trascurridas unas horas. Efectivamente el clavo desapareció y se recogió cobre, pero obsérvese el cambio de la disolución de azul a verde, lo que ocurrió fue simplemente una reacción red-ox.


Fig. 2 (izquierda). Facsímile del libro “El arte de los metales”. Fig. 3 (derecha) Reproducción actual del experimento de Alonso.
El cobre precipitó y el hierro pasó a la disolución. Estas dos reacciones lo explican
Cu2+aq + 2e- → Cu
Fe → Fe2+aq + 2e
es decir, que en resumen no ha habido transmutación sino un simple intercambio de electrones.
Hoy la química para "hacer algo" se resume bajo los nombres de química técnica o química industrial. También "hacen algo" los farmacéuticos y mucho de lo que diremos es aplicable a ellos, pero se consideran como campos aparte. Lo cual no es obstáculo para que un químico desarrolle su profesión en un laboratorio farmacéutico.
¿Qué aspectos particulares tiene la química industrial?
Obviamente las leyes de la química y la termodinámica son las mismas sin embargo hay diferencias sustanciales:
- La escala y los órdenes de magnitud, en el laboratorio en general se trabaja con cantidades pequeñas, del orden de los gramos, en la industria se trabaja con grandes cantidades, del orden de los centenares de kilogramos, incluso de toneladas de reactivos y productos.

Fig. 4. Planta petroquímica. Modelo de industria química pesada.
- La calidad de reactivos, en el laboratorio normalmente se trabaja con sustancias puras o casi puras, en la industria se trabaja con materias primas.
- Lo mismo cabe decir de los productos, además muchas veces la pureza que se exige en estos puede no ser muy rigurosa, así por ejemplo no es lo mismo preparar un ácido clorhídrico para uso de laboratorio que para preparar un "sal fuman" como desatascador.
- Las variables, en la industria al revés que en el laboratorio las variables económicas tienen la misma categoría o mayor que las variables fisicoquímicas.
Estas diferencias desembocan en otras por ejemplo el almacenamiento y transporte de productos y reactivos.
Diseño de reactores y sus elementos periféricos
Precisamente tanto el transporte de reactivos y productos como el propio diseño de los reactores y los diversos sistemas de calentamiento o evacuación del calor requieren un dominio de las leyes físicas correspondientes.
Productos y reactivos suelen presentarse en forma fluida, líquidos y gases, o pulverulenta y para su manejo se utilizan las leyes de la mecánica de fluidos que el ingeniero químico debe dominar. Concretando en la química propiamente dicha:
- Hay que tener en cuenta que procedimientos que funcionan muy bien en el laboratorio para un determinado objetivo, pueden no ser válidos en la industria y viceversa.
- Se debe controlar muy bien la cinética química, es decir, la velocidad con que se producen las reacciones y las condiciones termodinámicas que pueden modificarlas.
- Tiene gran importancia los residuos y vertidos. En laboratorio son fáciles de controlar y de eliminar mediante campanas de gases, contenedores para llevar los residuos a un punto limpio, sin embargo, en la industria:
- Las cantidades de residuos son muy grandes.
- Pueden contener todavía productos de interés que deberían recuperarse.
- Pueden ser peligrosos para el medio.
- Su eliminación correcta en el mejor de los casos cuesta dinero.

Fig. 5. Un viejo horno alto que transforma el mineral de hierro en hierro. Es uno de los más antiguos reactores industriales de régimen continuo.
- La ingeniería química es también una actividad económica y debe sacarse a los procesos el máximo rendimiento por tanto la economía de los procesos debe cuidarse al máximo y evaluar los costes de todo el proceso incluido transporte, almacenamiento, eliminación de residuos además tener en cuenta que estos pueden contener productos valiosos que no deben desaprovecharse.
¿Cómo se trabaja en la industria química?
Cada industria tiene su metodología, aquí se dan unas normas generales. Que más o menos son aplicables en términos generales. Tenidos en cuenta todos los puntos que se han tratado antes, el procedimiento suele empezar por el diseño de la reacción o reacciones que interesan. Luego se hacen las pruebas necesarias a escala de laboratorio. A la vista de los resultados se estudia si la extrapolación a mayor escala, considerados todos los aspectos, es posible y rentable. Entonces lo normal es iniciar las pruebas en planta piloto. Si los resultados son los esperados, se produce el paso a escala industrial y se inicia la producción definitiva.
¿Cómo trabajan los grandes reactores?
En química industrial se opera en general de dos maneras: por cargas, los reactivos se introducen en un gran reactor y se espera a que se produzca la reacción, se vacía el reactor se separan productos y restos y se recarga de nuevo el reactor, y en proceso continuo, se trata de reactores en los cuales por una parte entran los reactivos y avanzan a lo largo del reactor mientras transcurre la reacción. Estos reactores son se paran nunca y en ellos es más fácil por ejemplo establecer recirculaciones.
En resumen
La química industrial es un mundo impresionante en el que confluyen la química, la física y la economía. A partir de materias primas producen sustancias transformadas que luego se utilizaran, ya sea directamente, ya como materia prima, en otras industrias. Realmente sin darnos cuenta todos los días usamos decenas de artículos que han requerido la existencia de uno o varios procesos de química industrial. Por ejemplo, usamos jabón y perfumes, nos vestimos con tejidos sintéticos que posiblemente no hace mucho fueron petróleo, y que han sido teñidos con tintes sintéticos. Los artículos metálicos que usamos salvo unos pocos metales proceden de minerales de los que se han obtenido los metales, muchos de los artículos que utilizamos son de plástico. El agua ha sido tratada con productos químicos para garantizar su salubridad, el cuero de nuestros zapatos ha sido curtido con productos "químicos"… y todavía no hemos salido de casa. Así de importante es la industria química.
José Antonio Martínez Pons
Doctor en Química
Licenciado en Física
¿Cómo voy a querer ser de mayor quimiómetra, si no sé lo que es? Esta pregunta te la puedes hacer prácticamente con cualquier opción profesional que te sugiera tu entorno escolar, familiar o social. Incluso en profesiones como médico, abogado, biólogo, etc., que parecen estar bien definidas, encierran multitud de aspectos y matices que difuminan su concreción en un proyecto vital. Concretar cómo se quiere ser científico es una historia de profundización en uno mismo. Se trata de recorrer individualmente las tierras interiores que nos han tocado en suerte, y ahí barrenar buscando más allá del conocimiento consolidado. El mapa para hacer este recorrido es la metodología científica y los procedimientos de investigación. Pero el mapa describe el terreno, no es el terreno. Hay que estar permanentemente alerta para que la historia científica que cada uno construye tenga la suficiente fuerza inventiva para llegar más allá de donde acaba la señalización tranquilizadora del mapa.
¿Qué es esta rama de la ciencia llamada Quimiometría?
Empezaba yo en la Universidad por los años en los que esta disciplina comenzaba su andadura, por supuesto que en esos años, mil novecientos setenta y pocos, no era consciente de que me gustaba ser quimiómetra. Sólo una cosa tenía clara, me gustaban mucho las matemáticas, los números y sobre todo querer saber más de la ciencia en general. Por razones que no vienen al caso entre las disciplinas, de ciencias, que me hubieran podido interesar sólo puede optar a cursar Química. Comencé siendo aprendiz de química, me enteré que la Química se subdividía en otras cuatro disciplinas: Orgánica, Inorgánica, Químico-Física y Analítica, cada una de ellas explora y estudia aspectos muy distintos de la materia desde el punto de vista químico. Mi camino se fue cada vez acercando más a los números, a la información que estos proporcionaban, mi especialidad era la Química Analítica y en ella comencé a investigar siempre tratando de adentrarme en ese mundo que ahora ya sabía que se llamaba Quimiometría. En 1975 [1,2] se acuña la palabra Quimiometría y se propone su definición como:
"Una disciplina química que usa métodos matemáticos, estadísticos y lógica formal para: i) diseñar o seleccionar procedimientos experimentales óptimos; ii) Obtener la máxima información relevante contenida en los datos químicos".
La Quimiometría, es una ciencia aplicada, un quimiómetra puede tener ideas bellas, lógicas, elegantes, imaginativas, innovadoras pero carecen de valor si no son aplicables al entorno disponible, sólo son buenas si ‘trabajan’. Por ello, cada cuestión ha de responderse en los términos en que se nos plantea. Es mucho mejor dar una respuesta aproximada a la cuestión correcta que una respuesta exacta a la cuestión equivocada decía J.W. Tukey. Cuando interroga a la realidad química, el quimiómetra maneja modelos, G.P.E. Box decía que todos los modelos eran falsos pero que algunos eran útiles. Se trata siempre de ‘adecuar el modelo al problema’, buscando modelos altamente predictivos. Como consecuencia, la preocupación permanente del quimiómetra es conseguir que sus predicciones sean reproducibles. Toda rama respetable de la ciencia tiene su teoría -una colección de leyes axiomas, corolarios y reglas- que guía al científico en el uso de los experimentos para descubrir los secretos de la naturaleza. Como sugiere el dicho ‘la teoría guía, el experimento decide’ teoría y experimentación se interfieren y apoyan mutuamente en cualquier desarrollo científico. A quien se enfrenta por primera vez a la Química Analítica, se le describe el análisis químico en su perspectiva más amplia (análisis químico cuantitativo, cualitativo, medioambiental, etc.). Además, como es una ciencia metrológica y las medidas tienen incertidumbre se arma al estudiante con un curso de estadística elemental. A partir de aquí se le instruye en un montón de técnicas analíticas examinando los fundamentos físicos y químicos que subyacen a la instrumentación que posteriormente utilizará. Sin embargo, poco o nada se decía en las décadas de los 70-80 de cómo obtener información relevante de los datos químicos y menos aún cómo utilizar la misma en la toma de decisiones; ser capaz de tomar decisiones en ambiente de incertidumbre se ha convertido en uno de los retos más importantes del quimiómetra. En 1994 Books and Kowalski [3] muestran que existe una teoría guía de la Química Analítica. Esta teoría se usará para especificar exactamente qué información se puede extraer de los datos proporcionados por cualquier instrumento o método analítico. Servirá para guiar al químico en la optimización de las herramientas analíticas existentes y también para dirigir la investigación analítica que intenta construir herramientas más poderosas. Esta teoría habla del orden de la señal, porque tener números es una cosa, entenderlos e interpretarlos correctamente otra (T.N. Goh). Se necesita "crear" orden en los datos, detectar y modelar las estructuras subyacentes y esto es lo que sabe hacer un quimiómetra.
¿Qué es el orden de la señal?
Una de nuestras principales labores es determinar la cantidad de una sustancia ya sea esta una droga, pesticida o cualquier otra sustancia química de interés esto se hace con una función de calibrado y por ello los quimiómetras decimos que somos calibrado-dependientes. Los instrumentos químicos son cada vez más complejos, permiten obtener en poco tiempo un sinfín de datos. Si al medir una determinada sustancia en el laboratorio obtenemos un único número decimos que la señal es de orden cero, por ejemplo, cuando se mide el pH de una disolución. Cuando al medir en un espectrofotómetro, una muestra, obtenemos un espectro que es un vector, tenemos una señal de orden uno. Y si al hacer estas medidas disponemos de un instrumento aún más complejo como puede ser un cromatógrafo acoplado a un detector de masas (CG-MS, lo habrás visto en las series de TV cómo CSI en las Vegas) lo que tenemos es una matriz de datos por cada muestra medida. Es una señal de orden dos. Los instrumentos pueden proporcionar tantos datos que hacen falta algoritmos potentes para extraer la información adecuada de los mismos.
Cuando los calibrados se hacen con señales de orden dos, por cada muestra se tiene una matriz de datos, los cuales se estructuran de una forma muy original, cada patrón de calibrado es una matriz de estos datos a la cual se concatenarán las de otros patrones en el rango de concentración que nos interesa. Al final, se tiene un cubo de datos (lo llamamos tensor). Con este cubo, aplicando algoritmos muy potentes, se construye un modelo de calibrado de tres vías. Cuando se nos pide que determinemos la cantidad de un pesticida que hay en algún producto alimentario se aplicará el modelo de tres vías a la matriz de datos registrada para dicho producto. Además de la cuantificación se tiene la identificación inequívoca del analito incluso si en la muestra problema hay otros analitos interferentes que no estaban en los patrones de calibrado. Es obvio que esto ocurrirá siempre que se manejen muestras complejas y legalmente es mandatorio identificar inequívocamente y cuantificar sustancias prohibidas o con límite máximo como son drogas de abuso, residuos tóxicos procedentes de tratamientos veterinarios, pesticidas, sustancias que migran desde los materiales destinados a estar en contacto con los alimentos, etc. Otro ejemplo que ilustra la potencialidad de los calibrados de tres vías, es la información obtenida con la técnica de fluorescencia de excitación-emisión. Con ella, por cada medida también obtenemos una matriz de datos formada por los espectros de emisión registrados a varias longitudes de onda de excitación. Los patrones de calibrado forman la tercera vía del cubo. En este caso no nos limitamos a considerar que en la muestra problema hay una sola sustancia fluorescente, sino que hay varias que lo son (por ej. tres pesticidas). El problema es que el fluorímetro proporciona como señal la envolvente de toda la intensidad fluorescente de la muestra. Tenemos que ser capaces de separar la fluorescencia que pertenece a cada pesticida. Hay algoritmos que hacen esto estupendamente, por eso a estas técnicas matemáticas que separan sustancias cuando el instrumento químico no lo hace se las llama de ‘separación matemática’ por analogía con lo que hacen las técnicas químicas de separación cromatográfica.
Otras ocupaciones de un quimiómetra
Otros desafíos interesantes para el quimiómetra están relacionados con el ‘Reconocimiento de Pautas’. Las muestras reales son objetos complejos, su caracterización no puede hacerse determinando una única variable, por su naturaleza deben ser descritos de forma multivariante. Como experto en ‘Análisis de Datos’ el quimiómetra tiene unas capacidades transversales que utiliza para identificar objetos químicamente similares, detectar fraudes, descubrir estructuras subyacentes en grandes conjuntos de datos, clasificar objetos en base a múltiples medidas químicas y/o sensoriales. Mención especial merece la capacidad de hacer modelos de categorías, por ejemplo para definir la los niveles de calidad de alimentos a partir de determinaciones multivariantes sobre ellos; en este caso es relevante proporcionar en predicción la probabilidad de dar una falsa no conformidad y una falsa conformidad y llegar a un equilibrio entre ambas.
El quimiómetra también se ocupa de la optimización de procesos industriales y de procedimientos en el laboratorio. Utilizará la metodología del diseño de experimentos para obtener la información requerida del modo más eficiente y con la mayor precisión posible. Esta metodología permite reducir costes y ahorrar reactivos tóxicos lo que redunda en un mayor cuidado del medio ambiente.
Referencias:
[1]B .R.Kowalski, Measurement Analysis by Pattern Recognition, Anal Chem, (1975), 47, 1152A-1162A.
[2]B. R.Kowalski, Chemometrics: Views and Proposition, J Chem Inf Comput Sci, (1975), 15, 201-203.
[3] K..S. Booksh, B. R. Kowalski, Theory of Analytical Chemistry, Anal Chem, (1994), 66, 782A-791A.
María de la Cruz Ortiz Fernández
Doctora en Química.
Profesora de Química Analítica en la Facultad de Ciencias.
Catedrática de Química Analítica de la Universidad de Burgos.
La Tecnología de Alimentos en el origen de la civilización
Nuestra especie tiene unos 100.000 años de antigüedad, apenas un suspiro desde que se originó la vida en nuestro planeta hace al menos 3.800 millones de años. En ese tiempo hemos crecido hasta ser más de 7.500 millones de personas, y todos necesitamos alimentos. El principal aumento demográfico se ha producido en los últimos dos siglos y ha ido acompañado de grandes avances en ciencia y tecnología, cambiando como nunca antes, nuestra forma de relacionarnos, trabajar o alimentarnos. Pero si tuviera que citar el avance de la humanidad más relevante, el que probablemente ha hecho posible todos los demás, me remontaría hasta hace unos 8.000 años y señalaría, sin dudarlo, a la agricultura. La justificación es sencilla, la agricultura, junto con la ganadería, permitieron al ser humano tener el control de las fuentes de alimentos, establecerse alrededor de las zonas de cultivo y dedicar parte del tiempo a otras cuestiones no directamente relacionadas con la obtención de alimento, como la filosofía, la ciencia y el arte. En definitiva, la agricultura posibilitó la creación de todas las culturas y civilizaciones y alcanzar las cotas de desarrollo científico, tecnológico y artístico que tenemos en la actualidad. La prueba de ello son las muchas civilizaciones que a lo largo de la historia han colapsado cuando cayó su producción agrícola. Fue en ese instante, en el que el ser humano se estableció en un lugar para producir su propio alimento, cuando además de agricultor se hizo tecnólogo de alimentos.
De la materia prima al alimento
Ser capaz de producir tu propio alimento acarrea nuevos retos que hay que solventar, los que surgen al tratar de controlar y sacar buen rendimiento de los cultivos y los animales de granja, protegiéndoles de plagas, enfermedades y condiciones climatológicas adversas, y los que surgen de la necesidad de transformar y conservar los alimentos obtenidos para consumirlos durante los periodos en los que no hay producción. De mejorar y controlar los aspectos relacionados con la producción de las materias primas, fundamentalmente vegetales y animales, se encargan hoy en día ingenieros agrónomos y biotecnólogos.

Fig. 1. La Tecnología de Alimentos engloba todos los procesos que sufren las materias primas hasta convertirse en alimentos, desde los menos procesados como la fruta, o la carne fresca hasta los más procesados como las conservas, los precocinados o los fermentados.
El trabajo del tecnólogo de alimentos comienza en el instante inmediatamente posterior a la cosecha en el caso de vegetales, del sacrificio en el caso de animales o después de recolectar los productos de origen animal como la leche o los huevos. Todo lo que les ocurre a las fuentes alimenticias, a partir de ese momento y hasta que se convierten en los alimentos que se comercializan, es de lo que se encarga la Tecnología de Alimentos y su objetivo básico es el de proporcionarnos alimentos sanos, seguros y nutritivos (Fig. 1).
El tecnólogo de alimentos debe, en primer lugar, conocer los alimentos, su composición y sus propiedades, es decir, debe tener buenos conocimientos de Ciencia de los Alimentos. La aplicación de estos conocimientos al tratamiento práctico de las materias primas para convertirlas en los más variados productos alimenticios es lo que conforma el trabajo del tecnólogo de alimentos.
Evitar el deterioro de los alimentos y algo más
Probablemente una de las primeras cosas que aprendió el ser humano cuando comenzó a guardar alimentos para su consumo en diferido, es que se estropean y que, en consecuencia, disminuye su calidad y su seguridad hasta el punto de dejar de ser comestibles e incluso ser causa de infecciones o intoxicaciones. Por eso, las técnicas más básicas de conservación como el secado, la salazón o el ahumado se empleaban en las más antiguas civilizaciones conocidas. Hoy en día sabemos que el deterioro de los alimentos se debe al crecimiento de los microorganismos y a ciertas reacciones químicas y bioquímicas. Así hemos aprendido como detener o ralentizar estos procesos mediante la aplicación de técnicas de conservación. Las más usadas se basan en la aplicación del calor o del frío y en la deshidratación, existiendo múltiples variantes en función de la intensidad de los tratamientos aplicados y los objetivos perseguidos. Estos tratamientos se combinan a menudo con el control de la composición del alimento mediante el uso de determinados ingredientes y aditivos conservantes y con las diferentes formas de envasado, como el uso de atmósferas protectoras o al vacío. El uso de una determinada técnica de conservación tiene como primera consecuencia establecer cuál va a ser la vida comercial o vida útil del alimento y, por tanto, condiciona también sus posibles usos comerciales. Todas las técnicas de conservación pueden alterar, en mayor o menor medida, las propiedades del alimento, por lo que es misión del tecnólogo de alimentos, elegir la más apropiada para obtener un producto seguro, con la mayor calidad organoléptica y nutricional y con un coste asumible. Las operaciones tecnológicas aplicadas en la industria alimentaria pueden ser muy variadas tanto en sus objetivos como en su complejidad y proporcionar desde un producto fresco para su consumo en unos pocos días hasta los productos más procesados pero aptos para consumir durante una expedición de varias semanas al Everest o para alimentar a los tripulantes de la Estación Espacial Internacional.
Por otro lado, los microorganismos no son siempre un problema, existen múltiples alimentos fermentados en cuyo proceso de obtención participan activamente bacterias, levaduras o mohos. Muchos de estos alimentos, como la cerveza, el pan o el queso, aunque se elaboran desde hace milenios, siguen suponiendo en la actualidad un campo muy activo de innovación tanto por la búsqueda y obtención de nuevos y mejores microorganismos fermentadores, como por la generación de nuevos productos fermentados. Además, en ocasiones, un alimento fermentado, como por ejemplo un yogur, actúa como vehículo de microorganismos vivos que alcanzan nuestro intestino y que desde hace más de un siglo se han relacionado con propiedades beneficiosas para nuestra salud.
Producir una gran variedad de alimentos
Si un objetivo básico de la Tecnología de Alimentos es garantizar la seguridad de los alimentos que nos comemos, otro no menos importante es ofrecernos una gran diversidad de productos que se puedan ajustar a las distintas necesidades y coyunturas de la sociedad. Los cambios en los estilos de vida que se han dado en los últimos años, fundamentalmente en los países desarrollados, han dado lugar a nuevas demandas de calidad tanto organoléptica como nutricional, así como a productos alimenticios con nuevos usos. Por otro lado, se debe mejorar la oferta de alimentos para individuos con necesidades nutricionales especiales, como por ejemplo los celiacos o los intolerantes a la lactosa. Para responder a estas demandas actuales y futuras es y será imprescindible la apuesta por la investigación, el desarrollo y la innovación en todas las disciplinas relacionadas con la Tecnología de Alimentos. Esta es la vertiente más creativa del tecnólogo de alimentos que, por un lado, debe estar en contacto permanente con las demandas de la sociedad, incluso tratando de anticiparse a ellas, y por otro, debe estar al tanto de los últimos avances en ciencia y tecnología. Actualmente, por ejemplo, se investiga en nuevos sistemas y materiales para el envasado de alimentos, nuevos procesos de conservación más eficaces y con menor impacto en el producto y en el medio ambiente o la generación de nuevos productos con mejoras nutricionales y saludables.
El futuro de la Tecnología de Alimentos
Las necesidades de los países desarrollados son muy diferentes de las de los países en vías de desarrollo y el reto de la Tecnología de Alimentos es tratar de dar respuesta a todas ellas. Mientras en los países desarrollados se investiga en aplicaciones basadas en la nanotecnología o en envases activos e inteligentes, en los países en vías de desarrollo los retos sieguen siendo los más básicos, como garantizar el suministro de alimentos sanos, seguros y nutritivos y encontrar formas de enriquecer nutricionalmente y alargar la vida útil de los alimentos. Para lograr abastecer a una población que se espera que alcance los 9.000 millones de personas antes del año 2.050, va a ser muy importante aprovechar al máximo los recursos nutritivos de los alimentos, así como encontrar y explotar nuevas fuentes de obtención de nutrientes como las algas o los insectos.
Por otra parte, estamos inmersos en un desafío en el que toda tecnología, incluida la alimentaria, debe concebirse y aplicarse con la mirada puesta en reducir el impacto medioambiental, desde la producción de las materias primas a su transformación en alimentos más o menos procesados. En todos los rincones del planeta los tecnólogos de alimentos trabajan para dar soluciones a todos estos retos y avanzar en un mundo en el que, no lo olvidemos, gozamos actualmente de la mayor variedad, calidad y seguridad alimentaria de nuestra historia.
José Vicente Gil Ponce
Doctor en Ciencias Biológicas
Profesor Titular, Área de Tecnología de Alimentos, Universitat de València
El estudio de los virus es necesario para entender las enfermedades que éstos producen en el ser humano y también en otros seres vivos. Animales, plantas e incluso bacterias tienen que luchar contra los virus. Catarro, gripe, hepatitis, sarampión, SIDA entre otras, son enfermedades humanas causadas por virus. Sin embargo, el objetivo de este capítulo es destacar que la virología puede ser mucho más que el estudio de las enfermedades que los virus producen. Los virus son sobretodo modelos de trabajo para el estudio de procesos biológicos de forma sencilla. Es por esto que el estudio de los virus jugó un papel esencial en el desarrollo de la biología molecular, que es la base de la biología y la biomedicina modernas.
Algo de historia.
A mediados del siglo XIX, el químico francés Louis Pasteur mantenía una importante disputa sobre el origen de los seres vivos. Pasteur defendía que todo ser vivo, incluidas las bacterias, provenía necesariamente de otro ser vivo anterior, en contra de los defensores de la "generación espontánea", que defendían que ciertas formas de vida animales y vegetales podían surgir a partir de materia orgánica. Aunque no fue el primero en demostrarlo, los experimentos de Pasteur se consideran como la demostración definitiva de que la generación espontánea no existe, lo que le sirvió para crear su denominada "teoría germinal" de las enfermedades infecciosas, según la cual las enfermedades infecciosas están causadas por gérmenes o microbios invisibles, pero presentes en un organismo enfermo y que pueden así propagarse a otros individuos sanos.
Charles Chamberland, que era asistente de Louis Pasteur, diseñó un filtro de porcelana por el que no podían pasar bacterias para esterilizar agua. Pronto se dieron cuenta de que había agentes patógenos, que inicialmente denominados "virus filtrales" que podían atravesar el filtro. Esto dio lugar al descubrimiento de la toxina del tétanos y la difteria, que si bien son moléculas pequeñas producidas por bacterias, pueden ser tóxicas en sí mismas, aunque no propagables (no se contagian) de un organismo a otro. Algo más tarde, el filtro de Chamberland-Pasteur, sirvió para demostrar la existencia de agentes infecciosos (es decir, contagiosos) más pequeños que las bacterias, los denominados virus. En 1892, el botánico ruso Dmitri Ivanovsky demostró que el agente causante de la enfermedad del mosaico en la planta del tabaco, descrito poco antes por Adolf Mayer, podía atravesar el filtro, lo que supuso la primera demostración del concepto de virus tal y como lo entendemos hoy día. Además, a principios del siglo XX también se aislaron los primeros bacteriófagos, virus que infectan bacterias, por Twort (1915) y D´Herelle (1917).
Sin embargo, la virología contaba entonces con herramientas muy rudimentarias y los avances eran escasos. Esto cambió de forma radical en la segunda mitad del siglo XX. A partir de fines de los años 30 del siglo XX, varios investigadores provenientes de diferentes disciplinas científicas se formularon preguntas esenciales en relación a cómo definir la esencia de la vida y, en concreto la naturaleza de la información genética y los mecanismos de transmisión de la herencia. Así se inició un período revolucionario que tendría su culminación en el descubrimiento de la doble hélice del ADN por Watson y Crick en 1953. Así, en la década de los 30 un grupo de físicos liderado por Niels Bohr y Erwin Shrödinger se centraron en tratar de explicar biología y herencia. En concreto, el libro What is Life? (1944) de Shrödinger fue de gran inspiración para varios de los fundadores de la biología molecular.
El verdadero punto de inflexión fue el aislamiento del fago λ (lambda) por Esther Lederberg a principio de los años 50 a partir de un lisado de la bacteria Escherichia coli tratado con luz UV. Por la facilidad para aislar mutantes, λ fue usado por muchos laboratorios para la elaboración de mapas genéticos y pronto se convirtió en un modelo de trabajo versátil y cómodo, con el que se realizaron los primeros experimentos de biología molecular.
Así, gracias al fago λ y a otros modelos posteriores, se llegó a la descripción código genético y el ARN mensajero, los mecanismos básicos de la replicación del ADN y la recombinación genética, etc.
En el año 1972 se publicó la obtención de la primera molécula de ADN recombinante, que contenía algunos genes de λ y de su hospedador dentro del genoma del virus humano SV40, por el laboratorio de Paul Berg en la Universidad de Stanford. Así, en gran parte gracias a la investigación en virología, en la década de 1970 el mundo de la Biología comenzó a transformarse debido a la "Revolución del ADN recombinante", con la cual se podía introducir genes de cualquier organismo (sin importar su complejidad) en el material genético de otros organismos. Esta revolución provocó profundos cambios en las investigaciones con bacteriófagos, al igual que en otras áreas de la biología. Por poner solo algunos ejemplos, algunos virus como los lentivirus y otros se han utilizado para la expresión de proteínas ajenas en células (proteínas recombinantes), lo que puede utilizarse tanto para la obtención de vacunas como para desarrollo de terapia génica.
Cuarenta años después de contribuir al desarrollo de la biología molecular, los bacteriófagos viven hoy una segunda juventud. Por un lado, la utilización de virus bacterianos o alguna de sus proteínas para tratar enfermedades infecciosas causadas por bacterias es una alternativa al uso de antibióticos. Por otro, la batalla entre virus y bacterias a lo largo de la evolución ha dado lugar al sistema de inmunidad denominado CRISPR/Cas, que ha supuesto un auténtico punto de inflexión en la capacidad de modificar a la carta el genoma de casi cualquier organismo.
Mi propia experiencia
Yo casi siempre tuve claro que quería estudiar biología y en concreto dedicarme a la biología molecular. En ningún momento, ni antes, ni durante mi Licenciatura en Biología pensé que los virus tuvieran nada que me pudiera resultar interesante. Esto era normal porque mi único contacto con los virus fue un breve bloque de dos o tres temas de la asignatura Microbiología General que cursé en el tercer curso, allá por el año 1999/2000 en la Universidad de Extremadura (Unex).
Tras acabar la universidad pasé más o menos un año buscando un laboratorio en el que poder realizar una tesis doctoral para dedicarme a la investigación. Durante este tiempo realicé una tesina en el Departamento de Bioquímica de la Unex, trabajando en enzimología. Así fue como un proyecto de bioquímico con ganas de aprender biología molecular se topó por primera vez con un virus, en este caso, el VPPA o virus de la peste porcina africana. El VPPA es un virus de gran interés por la enfermedad que produce. Entre los años 1960 a 1980 el virus produjo graves pérdidas económicas en la cabaña porcina en Europa y América y brotes recientes en el sur de Rusia y otros países caucásicos mantienen aún hoy la enfermedad en la lista de las más peligrosas de la UE. Personalmente, reconozco que a mí los virus me parecían una cosa muy rara, sin demasiado interés para un bioquímico. No obstante, mi tesis iba sobre el papel de unas enzimas que codificaba el virus implicadas en la reparación de su ADN, por lo que el trabajo me pareció interesante y, sobretodo, en aquel momento era mi única opción.
Pronto me di cuenta que los virus son por encima de todo un fantástico modelo de trabajo, de los mejores que uno puede tener si le gusta hacer cosas diferentes. Esto es especialmente importante durante el doctorado, que debe ser, por encima de todo, una etapa de formación. Así, en los primeros meses de mi tesis me encargaron realizar un anticuerpo contra una de las proteínas del virus. Aún recuerdo esta etapa como sorprendente para mí. A partir de bacterias a las que habíamos introducido nuestro gen viral, pudimos purificar grandes cantidades de proteína "recombinante". Esta proteína se emulsiona con un aceite denominado adyuvante de Freund para hacer una especie de "mayonesa" espesa con la que se inocula a los conejos. De alguna manera, nuestra proteína sirve como "vacuna" para que el sistema inmune del conejo fabrique anticuerpos contra ella. Tras varias inoculaciones se obtiene el suero de la sangre del conejo con el que se puede detectar nuestra proteína tanto in vitro como dentro de la célula infectada.

Fig. 2. Imagen elaborada para la portada de mi Tesis Doctoral (Universidad Autónoma de Madrid, febrero 2009). Desde la estructura molecular del ADN del virus a la infección del cerdo.
En pocas semanas, aprendí a hacer experimentos de ingeniería genética, inmunología y biología celular gracias a mi virus.
Poco después comencé a trabajar con el virus, con el objetivo de generar virus recombinantes, mutantes para mi proteína, lo que también me introdujo en las técnicas de virología e ingeniería genética. Además de todo esto, también utilicé métodos de biología molecular y bioquímica para analizar las propiedades bioquímicas de mi proteína in vitro, es decir, mediante experimentos en un tubo de ensayo que me permitieron ver su efecto sobre fragmentos de ADN. En conjunto, independientemente de los resultados obtenidos, mi tesis me enseñó cómo trabajando con virus se pueden aprender diferentes técnicas científicas y estudiar un mismo problema desde distintas perspectivas. Aunque el VPPA es un virus complejo, es más manejable que un organismo vivo y se puede estudiar globalmente, desde múltiples perspectivas. Aunque el trabajo del científico tenga una utilidad a corto o largo plazo para la sociedad, los científicos nos movemos por la necesidad de aprender, de desentrañar los misterios de la naturaleza. Es por esto, que el trabajo con virus puede ser muy satisfactorio. En aquel laboratorio en el que hice mi tesis doctoral se estudiaba al VPPA desde todos los puntos de vista: el genoma del virus y su mecanismo de replicación y reparación, la formación de las partículas virales o morfogénesis y también los múltiples efectos de la infección sobre las células infectadas en el laboratorio y sobre los cerdos en el animalario.
Los años y los diferentes laboratorios por los que he pasado me han llevado ahora a seguir estudiando la replicación y reparación del ADN. Una gran parte de mi trabajo la llevo a cabo utilizando virus como modelo de trabajo, aunque ahora utilizo bacteriófagos, virus que infectan bacterias, mucho más sencillos que el VPPA. Pero igualmente, el uso de virus nos permite trabajar a la vez con un modelo in vivo y también trabajar in vitro con proteínas recombinantes purificadas.
En conclusión, yo de mayor quiero ser virólogo y así poder aprender todo lo que los virus me enseñen.
Bibliografía recomendada:
-. Cazadores de Microbios (Paul de Kruif, 1926)
-. La doble hélice (James D. Watson, 1968)
-. A la búsqueda del secreto de la vida. Una breve historia de la biología molecular (José María Valpuesta, 2008)
-. El origen de los sistemas CRISPR/Cas (Conferencia de Francisco Mójica en la Real Academia Nacional de Medicina, 26 de Enero de 2007)
Modesto Redrejo Rodríguez
Doctor en Biología
Centro de Biología Molecular Severo Ochoa
Durante los años previos a la universidad estuve totalmente desorientada y sin tener claro qué podía estudiar. Me gustaban las ciencias pero no tenía ninguna preferencia y no sabía por cuál decantarme. Todo cambió en el último curso, cuando mi profesor de ciencias de la tierra, a través de sus experimentos, me hizo disfrutar de cada una de sus clases y me descubrió una ciencia distinta a las clásicas matemáticas, física, química o biología que había estudiado hasta entonces. En esta ciencia se podían aplicar los conocimientos adquiridos en todas las demás ciencias experimentales que tanto me interesaban, abriendo ante mis ojos el abanico lleno de posibilidades que son las ciencias de la tierra y ayudándome a comprender que me quería dedicar al estudio de lo que más me había apasionado desde que era niña, lo más valioso que tenemos, nuestro hogar, nuestro planeta. Lo que jamás habría imaginado es que mi interés por la naturaleza y sus orígenes me llevarían tan lejos como hasta Marte, un planeta fascinante para el estudio de cambios en las condiciones ambientales.
Ciencias ambientales
Es una ciencia interdisciplinar cuyo objeto de estudio es el medio natural, que comprende el conjunto de componentes físicos, químicos y biológicos con los que interactúan los seres vivos. La persona graduada en Ciencias Ambientales recibe el nombre de ambientólogo y posee un conocimiento detallado de nuestro entorno.
Gracias a una formación multidisciplinar que le permite abordar los inconvenientes ambientales desde distintas perspectivas, el ambientólogo lleva a cabo tareas que pueden desempeñar especialistas de otras áreas, pero este lo hace de una manera integrada, teniendo en cuenta los puntos de vista de las diferentes ciencias, lo que le posibilita abarcar un amplio espectro laboral pudiendo dedicarse, por ejemplo, a la elaboración de auditorías medioambientales, al control y tratamiento de la contaminación acústica, atmosférica, de suelos y de aguas, al diseño de sistemas integrados de gestión, a la educación ambiental, a la energía, evaluación de impacto ambiental, gestión de recursos cinegéticos, forestales e hídricos, gestión de residuos, gestión de Espacios Naturales Protegidos, prevención de riesgos laborales, profesorado, investigación, sistemas de información geográfica y teledetección, entre otros.
El estudio del medio ambiente es esencial en los tiempos que corren, en los que existen multitud de problemas que afectan de forma negativa a nuestro planeta, tales como la fragmentación de hábitats, la incidencia de especies invasoras, el cambio climático, la deforestación, los incendios forestales, la contaminación del aire, agua y suelo, el ruido, los residuos, el uso de combustibles fósiles… a los que se debe poner solución. Para ello es necesario conocer el origen de estos fenómenos y aplicar medidas preventivas que eviten que se produzcan efectos adversos sobre el medio, correctoras que anulen o minimicen el impacto ya producido y compensatorias, que lo contrarresten.
Por ello, se puede afirmar que ser ambientólogo es una profesión fascinante. No es sólo la persona que estudia el entorno, es el médico del planeta, el que puede hacer un diagnóstico de los problemas y buscarles una solución mediante el empleo de modelos destinados a fomentar el desarrollo sostenible, que permitan satisfacer las necesidades de las generaciones presentes sin comprometer la capacidad de satisfacer sus necesidades a las generaciones futuras.
Ciencias planetarias
La planetología es una ciencia interdisciplinar y muy actual, desarrollada a partir de los avances en la carrera espacial y encargada del estudio del origen y evolución de los planetas.
Las ciencias planetarias mantienen una estrecha relación con las ciencias ambientales, ambas son ciencias interdisciplinares y además, las ciencias ambientales forman parte de las planetarias, ampliando estas últimas su objeto de estudio del planeta Tierra a todos los planetas, especialmente los correspondientes al sistema solar de los que se dispone de una mayor cantidad de datos.

Fig.1. Glaciares. A) Glaciar Breidamerkurjökull, Islandia. B) Morfologías lobulares localizadas en la mitad norte del monte central del cráter Gale, Marte.
Los avances en la investigación de otros cuerpos planetarios distintos a la Tierra me llevaron, hace ya algo más de tres años, a estudiar el medio ambiente, pero esta vez de Marte, utilizando los Sistemas de Información Geográfica como herramienta para dicho estudio, de la misma manera que se aplican al medio terrestre. Esto supuso para mí un desafío y una tarea muy gratificante dado que es algo extraordinario y que muy pocas personas tienen la suerte de poder disfrutar.
Es sorprendente el grado de detalle de las imágenes de la superficie marciana procedentes de orbitadores y más aún, su parecido con los paisajes terrestres, con los que comparten rasgos impresionantemente similares, como por ejemplo las lenguas glaciares (Fig. 1), o los campos de dunas (Fig. 2) entre otros.
A pesar de que no existen análogos perfectos, sí se han identificado lugares caracterizados por presentar condiciones parecidas a las marcianas respecto al clima, mineralogía, geomorfología o geoquímica.

Fig.2. Campos de dunas. A) Campo de dunas en Tatón, Argentina. B) Campo de dunas en el interior del cráter Trouvelot, Marte.
El estudio de análogos, muy novedoso y que sin lugar a duda reportará importantes descubrimientos, trae consigo grandes beneficios, entre ellos destacan la mayor facilidad en la investigación de Marte, solventando la imposibilidad de realizar análisis in situ sobre su superficie, reduciendo notablemente los costes que supondría enviar una misión al planeta y fomentando paralelamente una mejora en la comprensión de los ambientes terrestres.
A modo de conclusión
Cuando decidí decantarme por las ciencias ambientales mi objetivo principal era conocer mejor nuestro planeta para, de este modo, poder contribuir a mejorarlo. Siempre me había preocupado el estado de conservación en el que se encontraba la Tierra y había intentado aportar mi granito de arena siendo responsable con el medio ambiente, pero quise poder hacerlo a otro nivel y con una base científica que me proporcionara los conocimientos necesarios para ello. Lo que nunca imaginé es que podría llegar a estudiar otro planeta, lo que demuestra que la ciencia no tiene límites. Todavía no sé hasta dónde puede llegar un ambientólogo o qué puede alcanzar a descubrir. Es la magia de la ciencia, que nunca sabes hacia dónde te puede llevar.
¡Emprende la aventura de la ciencia!
Cristina Robas García
Graduada en Ciencias Ambientales
Estudiante Predoctoral Centro de Astrobiología CSIC-INTA
Me interesaban muchas cosas de las que se contaban en la escuela, pero creo que fue a los catorce años cuando decidí que de mayor quería ser astrofísica. No había teléfonos móviles, ni ordenadores en las casas, ni internet, así que escribí una carta postal al Ministerio de Educación y Ciencia para preguntar qué tipo de estudios tendría que cursar llegado el caso. No sé si me aclararon mucho o poco en la respuesta, pero gracias a una vecina maestra, que me consiguió un folleto con los planes de estudios superiores en España en aquel momento, entendí que tendría que cursar una "Licenciatura en Ciencias Físicas, con la Especialidad de Astrofísica" (cinco años de universidad en total) si quería lograr mi objetivo. Eso de estudiar física metía respeto, la verdad, pero no cambié de opinión porque el Universo tenía pinta de ser el contenedor de todas las respuestas. Y aquí estoy, y soy astrofísica…
Y sí, en astrofísica queremos entender cómo funciona el Universo. Entero y por partes. Todos los fenómenos observados, desde las tormentas solares hasta los exoplanetas, o la materia oscura, nos interesan. Y tenemos las leyes de la física, los continuos avances tecnológicos y el método científico para buscar y explicar las causas que están detrás de esos fenómenos observados. Por ejemplo: observamos que las estrellas brillan y queremos caracterizar y describir ese fenómeno, pero también necesitamos entender por qué una estrella brilla; qué pasa dentro de la estrella para que emita ese brillo que observamos. Por cierto, brillan mucho, porque son básicamente reactores termonucleares de fusión de hidrógeno al aire libre… Así con todo.
Hay por tanto muchísimos campos de estudio interesantes en los que trabajar en astrofísica y a veces es difícil decir que no a proyectos en los que se nos presenta la ocasión de colaborar. Yo mencionaré tres proyectos en los que colaboro, que son: el satélite Gaia de la Agencia Espacial Europea (la ESA), la evolución estelar en fases avanzadas y la astrobiología.
El satélite Gaia es sin duda una de las grandes misiones de la ESA para este siglo y sus datos ya están revolucionando nuestro entendimiento de la estructura y composición de la Vía Láctea, la galaxia en que vivimos. La planificación, ejecución y puesta en marcha de las misiones espaciales es siempre una tarea compleja y muy laboriosa, y que requiere de muchísima colaboración y coordinación entre personas e instituciones, antes y después del lanzamiento. En general, se divide todo el trabajo en paquetes que se distribuyen a los distintos grupos de investigación o de ingeniería.

Fig. 1. Impresión artística del satélite GAIA de la Agencia Espacial Europea. Créditos: © ESA–D. Ducros, 2013, fuente ESA, web ESA.
En Galicia, el Grupo Gallego para Gaia (GGG), es un grupo de investigación interdisciplinar en el que colaboramos astrofísicas e ingenieros informáticos de las universidades de A Coruña y Vigo desde hace más de diez años.
La misión Gaia proporciona ingentes cantidades de datos que necesariamente deben ser tratados y analizados masivamente por ordenador. Sería lo que se conoce hoy como un problema de Big Data. En nuestro grupo se aplican técnicas y algoritmos de inteligencia artificial y redes neuronales para el tratamiento de los datos de Gaia. Estas técnicas intentan reproducir en cierto modo el funcionamiento de un cerebro humano experto, analizando y tomando decisiones, pero en un ordenador y, en este caso particular, sobre datos astrofísicos. Gaia envía unos 60 GB de datos diarios, unos 600 millones de imágenes, así que realmente sería imposible procesar toda esta información "a mano".
En cuanto a la temática de la evolución estelar en fases avanzadas, colaboro en el estudio de las propiedades de un tipo de estrellas llamadas subenanas calientes (hot subdwarfs, en inglés) que están en una etapa de transición entre lo que sería nuestro Sol de hoy y su estado de muerte final en forma de enana blanca, dentro de unos 5000 millones de años. Todas las estrellas, como sabemos, nacen, evolucionan y mueren y, dependiendo fundamentalmente de su masa al nacer, van a seguir caminos evolutivos diversos, formando grupos poblacionales con ciertas características semejantes dentro de cada grupo en esas etapas a lo largo de sus vidas.
Pero hay miles de millones de estrellas en cada galaxia, imposible estudiarlas todas en detalle. Es importante por tanto caracterizar lo mejor posible las propiedades físicas y químicas de tantos objetos dentro de cada uno de estos grupos o clases estelares como se pueda para conocer los caminos evolutivos de las estrellas en sí, pero también, y esto es muy importante, para entender las conexiones evolutivas entre las distintas clases o etapas. Las subenanas calientes en particular muestran algunas características espectroscópicas peculiares que todavía hoy no se entienden bien, desde su descubrimiento en la década de 1940. En esta colaboración, entre otras técnicas, utilizamos las herramientas del Observatorio Virtual Español, cruzando catálogos y bases de datos astronómicos en diferentes rangos espectrales, para primero descubrir nuevos objetos candidatos a subenanas calientes, previamente no catalogados, y para luego determinar sus propiedades y parámetros astrofísicos, como son la gravedad o la temperatura.
En cuanto al campo de la astrobiología: yo soy profesora de física en el grado de biología de la Universidade de Vigo y cada curso le pregunto a mi alumnado si están de acuerdo con que una de las grandes preguntas científicas que la Humanidad tiene planteadas encima de la mesa es la de si hay o no vida en el Universo, fuera del planeta Tierra. Siempre estamos de acuerdo en que sí lo es, una pregunta muy importante. Hoy por hoy ya se están poniendo los medios para buscar vida, fundamentalmente vida bacteriana, en algunos cuerpos de nuestro Sistema Solar.
Pero, también, desde el descubrimiento hace más de 20 años de los llamados exoplanetas o planetas extrasolares, han sido vertiginosos los avances en materia del descubrimiento y caracterización de planetas similares a la Tierra orbitando a otras estrellas. En realidad ha sido vertiginoso el descubrimiento de todo tipo de exoplanetas, pero en particular se busca planetas de un tamaño parecido al de la Tierra, con agua en superficie, con atmósfera y situados a la distancia adecuada de su estrella madre (en la llamada zona de habitabilidad) como para poder albergar vida en alguna de las formas que conocemos de vida. En este campo, en colaboración con un colega especialista en rayos cósmicos, profesor de la Universidad de Santiago de Compostela y su equipo, queremos estudiar mediante modelos el impacto que esta radiación de partículas muy energéticas procedente de la estrella madre podría tener sobre la habitabilidad de sus planetas con atmósfera, para diferentes composiciones atmosféricas y diferentes valores de la aceleración de la gravedad del planeta, de manera similar a cómo se puede estudiar la incidencia de los rayos cósmicos solares sobre la atmósfera terrestre, o sobre la de Marte. Los rayos cósmicos son partículas fundamentales, como electrones o protones, a muy altas velocidades y que en el caso del Sol en particular pueden escapar cuando parte del campo magnético solar se reconfigura, emitiendo por ejemplo llamaradas ("flares").
Hasta donde sabemos, las leyes de la física son universales y por lo tanto rigen en todo el Universo. Y el Universo es todo lo que vemos, y lo que no vemos: el espacio, el tiempo, la materia, la energía y todas las interacciones entre estos elementos son los ingredientes que lo conforman. Así, abarca todas las escalas, desde las subatómicas hasta las extragalácticas y necesitamos diferentes leyes en los diferentes rangos. La mecánica cuántica para estudiar y comprender los sistemas físicos muy pequeños, o los principios de la cosmología para llegar a los confines del universo conocido.
También decimos que la astronomía moderna comenzó desde que, hace poco más de 400 años, Galileo apuntó un telescopio al cielo por primera vez. Los avances en nuestro conocimiento del Cosmos han sido enormes. A cada nuevo descubrimiento siguen siempre nuevas preguntas, a cada cual más compleja, y para observar cada vez más lejos, objetos cada vez más débiles y más antiguos hemos ido necesitando desarrollos tecnológicos cada vez más espectaculares, en tierra y en el espacio. Cuando yo estudié la carrera un telescopio de cuatro metros de diámetro de espejo primario era muy grande; hoy los telescopios de 10 metros se están quedando pequeños ante los planes de construcción de telescopios de 40 metros que ya hay en marcha. En la exploración espacial, no digamos la de cosas que se han conseguido. Y todos estos desarrollos tecnológicos e instrumentales revierten antes o después en la sociedad. Un ejemplo sencillo: todos los teléfonos móviles hoy llevan una cámara de fotos digital ¿no? Esas cámaras se desarrollaron en astronomía, para los telescopios.

Fig. 2. Vista panorámica del Observatorio del Roque de los Muchachos.
Créditos: IAC-Pablo Bonet (2011), fuente IAC, web IAC.
Y, realmente, conocer mejor el universo en el que vivimos y tomar conciencia de que nosotros formamos parte integrante de él, nos ayudaría a vivir mejor en la Tierra. Lo que se conoce, se aprecia y se siente como propio, se cuida, en general. El planeta Tierra también es parte del Universo; podríamos empezar por ahí, por cuidar el planeta. No hay recambio, ni hay de momento adonde ir si lo deterioramos de forma irreversible. Podemos pensarlo un poco.
Pero yo creo que el futuro de la astrofísica se presenta bien. España hace apenas 30 años contaba poco en el panorama de la astrofísica internacional y hoy creo que andamos por el séptimo puesto en publicaciones científicas y número de citas. Pero también la astrofísica española está bien situada en cuanto a participaciones tecnológicas nacionales e internacionales en proyectos muy complejos, espaciales y terrestres. O sea, podemos decir que hoy por hoy España está en el Top-Ten de la astrofísica mundial, con un futuro prometedor para seguir avanzando por esa línea. Ahí contribuimos lo mejor que podemos quienes nos dedicamos a esto y yo, la astrofísica, sin duda, os la puedo recomendar.
Ana Ulla Miguel
Doctora en Astrofísica
Profesora del Departamento de Física Aplicada
Área de Astronomía y Astrofísica, Universidade de Vigo
Escribo estas líneas desde mis treinta y tantos años. Echando la vista atrás y pensando en cómo he acabado en esta profesión tan exótica, la de astrofísico molecular, me vienen a la memoria momentos de mi adolescencia que se me han grabado a fuego. Recuerdo los veranos en el pueblo haciendo el salvaje. Me viene también a la memoria la tarde en que asesinaron a Miguel Ángel Blanco como una tarde irreal. ¡Qué mundo tan loco! Pero uno de los momentos que más me marcó en mi adolescencia fue cuando vi la película Contact, con Jodie Foster como intrépida astrónoma dando con uno de los hallazgos más gordos que uno pueda imaginar. Yo casi diría que se trataba de EL HALLAZGO con mayúsculas. Recuerdo que me atrajo poderosamente el aire distendido que parecía tener la profesión de astrónomo, con Jodie Foster al mando de un telescopio en un momento en que parecía haber dado con algo muy gordo, algo que nunca nadie había visto antes. La historia me absorbió por completo, sobre todo durante la primera parte. Sentía como mía la excitación de la protagonista al ser consciente de que el telescopio estaba captando una señal nada usual. Los nervios al ser consciente de que la posición del cielo de donde provenía la señal se ocultaría por debajo del horizonte en breve. Había que ponerse en contacto con otros observatorios del planeta para que continuaran observando la misma posición. Jodie Foster no podía permitirse perder la señal. ¿Quién sabe si mañana volvería a estar ahí? ¡Madre mía, qué momento! Para los que no conozcan la película, les diré que está basada en una novela de Carl Sagan, astrónomo y fantástico divulgador, y que el hallazgo en cuestión no es otro que el descubrimiento de vida inteligente en otro planeta. ¡Casi nada!
Cuento todo esto aquí porque ahora, echando la vista atrás, pienso que el haber visto aquella película en aquel momento influyó mucho para que luego acabara dedicándome a la investigación en astrofísica molecular. Que yo quería hacer algo parecido a lo que vi en esa película lo supe mucho más tarde. En aquel momento no podía ni intuir nada parecido, aunque el asunto dejó su semillita. Supongo que en realidad el devenir de uno es una mezcla de inquietudes personales y de casualidades. Yo en aquella época veía mi vida futura como algo muy lejano, muy incierto, y casi como que no tenía nada que ver con quien yo era entonces. Creo recordar que por aquella época quería ser futbolista. Nada original. Pero de vez en cuando ocurrían cosas como ésta de la película Contact que iban dejando semillas que más tarde habían de despertar.
Años después decidí estudiar Químicas, no por tener yo una gran vocación hacia la química sino por razones más bien pragmáticas. La química me parecía algo con una buena combinación entre ciencia básica (esto me gustaba) y ciencia aplicada, lo que ofrecía buenas opciones para trabajar en alguna de las muchas industrias químicas que pueblan el país (esto me dejaba un poco más tranquilo de cara al incierto futuro laboral, abandonadas ya mis pretensiones de ser futbolista). Además la facultad de ciencias en donde estudié Químicas estaba al lado de mi casa (esto me hacía la vida bien cómoda). Durante los años de universidad la vida transcurría entre períodos de tranquilidad y vida nocturna alternados con las temidas épocas de exámenes en que tocaba decir adiós a la vida alegre para encerrarse a estudiar hasta el agotamiento. No volví a tener mucho contacto con el tema del cosmos, más allá de lecturas ocasionales, alguna que otra conferencia que organizaba la asociación astronómica de la facultad de ciencias, y una exótica asignatura que cursé hacia el final con el sugerente nombre de Gravitación y Cosmología. La asignatura en realidad formaba parte de la carrera de Físicas pero por entonces, y supongo que ahora también, uno podía cursar unas pocas asignaturas de libre elección de cualquier carrera alejada de la química. Recuerdo que en alguna ocasión fantaseé con la idea de reorientarme hacia la astrofísica. Sabía que en Canarias existía un entorno muy estimulante para ello, pero me parecía que lo ideal hubiera sido estudiar Físicas y que con una formación química iba a resultar bastante complicado. La física era cosa de átomos y de procesos exóticos relativistas y por tanto parecía el camino ideal para estudiar el espacio, mientras que la química eran moléculas y reacciones en tubos de ensayo, vamos, una cosa más terrenal. Bueno, tenía que apechugar con la decisión de haber estudiado Químicas y no Físicas. Después del esfuerzo de sacar Químicas no me veía con energías para volver a empezar otra carrera. Además Físicas no parecía ser especialmente sencilla.
Pero ya acabada la universidad, ¡cuál fue mi sorpresa!, resulta que había moléculas en el espacio y existía gente que se dedicaba a estudiarlas. Di con esto de forma casual. Por aquel entonces comenzó a extenderse al común de los mortales el uso de internet. Yo apenas lo había utilizado pero me dio por buscar temas atractivos para quizá hacer una tesis doctoral, y di con una noticia por aquel entonces reciente que rezaba "astrónomos españoles detectan por primera vez benceno en el espacio". ¡Vaya! No solo resulta que en el espacio había moléculas familiares para un químico, sino que además había astrónomos españoles detrás del descubrimiento. El tema parecía muy atractivo. O sea que contacté por email a la persona que estaba detrás del asunto, que acabó siendo mi director de tesis, y comencé mi historia como astrofísico molecular.
La verdad es que me sentía un privilegiado al cobrar dinero por hacer algo que me resultaba tan interesante. La experiencia laboral que tuve hasta entonces consistió básicamente en los típicos trabajos temporales que uno hace para ganar algo de dinero y gastarlo el fin de semana. Esto de la astrofísica molecular era claramente más interesante. Ahora con más perspectiva, me sigo sintiendo un privilegiado, aunque, claro, he perdido algo de la inocencia de entonces y me doy cuenta de que esta profesión además de muy bonita es también muy dura por inestable. Uno se mueve mucho de un lado a otro y nunca sabe si en algún momento dejará de conseguir financiación y tendrá que dejar la ciencia para buscarse las habichuelas en otras aguas.

Fig. 1. A la izquierda, el radiotelescopio de 30 metros del Instituto de Radioastronomía Milimétrica (IRAM), situado en el Pico Veleta, en Sierra Nevada. En el rango del espectro en que observa, éste es, sin temor a exagerar, el mejor telescopio del mundo, ¡y está aquí al lado! La fotografía es de Aniceto Porcel. A la derecha aparezco junto a dos colegas (Miguel Ángel Requena Torres y Nami Sakai) en la sala de control del telescopio. ¡Grandes momentos he pasado ahí dentro!
Pero también tiene muchos aspectos gratificantes: viajes a lugares remotos y no tan remotos en que se conoce gente interesante, libertad para entrar y salir, pero sobre todo la satisfacción que te da trabajar en algo que te gusta y en que puedes poder poner a prueba tus propias ideas. ¡De vez en cuando alguna resulta ser una buena idea! Recuerdo con especial cariño la primera vez que fui a observar a un telescopio. Se trataba de un radiotelescopio que está en el Pico Veleta (Fig. 1), en Sierra Nevada, muy cerca de Granada. En una de las ocasiones en que fui sólo a observar recuerdo que traté de buscar una molécula que no se había detectado en el espacio. Se trataba de HCP, una molécula con un átomo de hidrógeno, otro de carbono, y otro de fósforo. Los modelos en que estaba trabajando durante la tesis parecían indicar que podía ser una molécula abundante. Tras un par de horas de observación eché un ojo a los datos sin mucha esperanza. Ya había intentado buscar otras moléculas en el pasado sin mucho éxito.
Pero vaya, ¡esta vez...! En la pantalla del ordenador apareció una señal en el espectro exactamente donde debería estar si se debiera a la molécula que buscaba. ¡Qué emoción, qué alegría, qué alboroto! Aquello fue lo más parecido que he experimentado al momentazo de Jodie Foster en su radiotelescopio particular. Obviamente, el descubrimiento de la molécula de HCP no daba para que el mundo girara su cabeza como lo hizo hacia la señal de Jodie Foster en Contact, pero la sensación de haber descubierto algo que nadie antes había visto fue increíble.
Aun sigo pensando que el HALLAZGO con mayúsculas será encontrar vida inteligente en otro planeta, y quiero pensar que ocurrirá pronto. Sólo espero estar aún aquí cuando eso ocurra.
Marcelino Agúndez Chico
Licenciado en Química y Doctor en Astrofísica
Instituto de Física Fundamental, IFF – CSIC, Madrid
Hay muchas motivaciones y muchos caminos para acabar siendo astrónoma. Nadie se levanta en la cuna gritando "¡Quiero ser astrónomo!," como parece leyendo la biografía de algunos astrónomos muy famosos. Pero una de las mejores cosas que te pueden pasar en la infancia es tener unos padres que te pongan en contacto con el fascinante mundo y los enigmas del cielo estrellado. El amor que los padres pueden transmitir hablando del cielo es algo que difícilmente una niña podrá olvidar en toda su vida. No todas pueden ser tan afortunadas, sin embargo hay otras maneras de tener los primeros contactos con la astronomía y con la ciencia en general.
Mi primer consejo es que no se debe tener miedo o inquietud ante de la ciencia. La ciencia no pertenece exclusivamente a una casta de seres superiores que viven en un mundo diferente. Aún cuando a los astrónomos en el pasado los vieron de ese modo. La ciencia es sobre todo un método, pertenece a quien puede aplicar este método con éxito. Y la astronomía ofrece un buen ejemplo que las contribuciones científicas son posibles para "ciudadanos" (citizen astronomy). Hay también muchas personas, astrónomos aficionados, que dedican una parte de su tiempo a las observaciones astronómicas, con instrumentación que es menos poderosa de la de los astrónomos profesionales, pero que pueden aportar contribuciones muy importantes. Para ser astrónoma, se necesitan los conocimientos de cómo utilizar esta instrumentación. Astrónomos son todos aquellos que tengan conocimientos y el sistema para hacer que sus ideas den lugar a resultados. No se necesita que los resultados sean completamente nuevos u originales. Hay más galaxias y estrellas en el cielo que astrónomos en la tierra. Y el cielo está en continuo cambio; muchas estrellas y núcleos de galaxias varían con el tiempo y cubren una escala de tiempo muy grande; los demás fenómenos de variabilidad no están bien comprendidos, y cada objeto puede ser diferente de otros objetos de la misma clase. También tenemos objetos del sistema solar, muy cercanos, y muy peligrosos, como los cometas y los asteroides que necesitan ser identificados y que requieren el cálculo de sus órbitas para estar seguros que no van a impactar con la tierra. Por lo tanto todo dato nuevo obtenido con el cuidado necesario casi siempre sirve para crear nuevos conocimientos astronómicos. Y parece obvio que la astronomía está relacionada con la supervivencia de la especie humana.
Yo creo que la astronomía satisface una necesidad básica de la humanidad. La medición del tiempo es una de esas necesidades. Incluso en la forma más primitiva, es algo que ayuda a los humanos a sobrevivir. En el pasado el "contacto" con el cielo era más frecuente y más importante que en la actualidad. La mayoría de las personas en Europa viven en ciudades cuyas luces ofuscan el cielo. El cielo no ofrece hoy la posibilidad de la medición del tiempo. Hay relojes mecánicos, electrónicos, atómicos, que han desplazado el papel del cielo como mediador del tiempo. De vez en cuando me pregunto qué haría en una isla tropical desértica, a miles de kilómetros del rastro más cercano de nuestra civilización. Creo que me sentiría abrumada por el cielo. El cielo parecería mucho más cercano. Me permitiría perderme en la contemplación de su belleza. Resolviendo las Pléyades a simple vista cerca de Orión, examinando los detalles más débiles de la Vía Láctea… Sin embargo, como señaló mi antiguo profesor de Astronomía y más tarde consejero de tesis de licenciatura, cuidado con el momento de la contemplación, que puede ser abrumador, puede durar mucho tiempo, pero no puede ser el final de todo. Debe ir seguido de la necesidad instintiva de intentar comprender la belleza del cielo. Entonces, lo primero sería probar algunas medidas. Primero construiré un simple reloj de sol, que me permitirá identificar la línea del meridiano y, por lo tanto, los puntos cardinales. Después, identificaré la estrella polar que identifica el polo norte celeste. Segundo, haré un agujero hueco en una caña de bambú con un soporte e intentaré medir la culminación y el camino de las estrellas nocturnas más brillantes. Estas mediciones me proporcionarán la capacidad de identificar mi dirección en el día y en la noche, así como también una afinada medición del tiempo y de la latitud del lugar sin instrumentos sofisticados. Estos son conocimientos esenciales que hacen que los humanos sean diferentes del resto de seres vivos del planeta, y nos liberan en parte de las reacciones, negativas, instintivas asociadas con los fenómenos celestes.
Desafortunadamente, ser mujer ha hecho las cosas inmensamente más difíciles durante la mayor parte de la historia de la humanidad. Justo porque la predicción exitosa de fenómenos astronómicos como los eclipses y por lo tanto el contacto con el cielo fueron considerados como algo sagrado (aún lo son, visto cómo se ven los astrónomos en la cultura popular) las mujeres fueron excluidas de convertirse en astrónomos en el sentido moderno del término. En la mayoría de los casos, solo fue posible por aquellas que pudieron tener la fortuna de relacionarse con astrónomos masculinos (Caroline Herschel, y su hermano, solo para citar un caso); pero algunas de ellas pagaron con su vida su dignidad intelectual (Hypatia de Alexandria que fue la hija del matemático Theon). Me extraña que una película sobre la vida de Hypatia y su muerte no se haya proyectado en mi país teniendo en cuenta que su muerte fue promovida por un santo de la iglesia católica. Las mujeres que dejaron los fundamentos de la espectroscopia astronómica en los primeros años del siglo XX (las "Harvard Computers") no se casaron. Hace dos generaciones en mi país todavía era muy difícil encontrar una mujer astrónoma o científica en general. Un par de generaciones atrás ser astrónoma implicaba un gran sacrificio, como no casarse y no tener hijos, y aquellas que se casaron usualmente debieron dejar el empleo.

Fig. 1. El equilibrio de género se logró en una reunión reciente en Padua, Italia, donde los participantes y los oradores, todos astrónomos profesionales o estudiantes, fueron mitad mujeres y mitad hombres (¡dentro de las fluctuaciones estadísticas esperadas!).
Ahora los tiempos han cambiado (Fig. 1). Ser astrónoma ya no es ser una pionera en los derechos de las mujeres. La mitad de los estudiantes de astronomía son mujeres. Eso no quiere decir que no haya problema de género. Hay muchos problemas de género, y los que son más difíciles de solucionar son los relacionados a la mentalidad machista de algunos astrónomos que sin embargo permanecen en prestigiosas posiciones académicas. Y también las propias astrónomas se someten a los esquemas mentales machistas por facilitar su carrera. Pero no es una lucha como la de las pioneras, que sufrieron también de un estigma social.
En relación a esta discriminación residual, yo no me preocuparía, hay mucho por delante de nosotros. Ahora y en las próximas décadas habrá momentos mágicos para la astronomía. Antes de la mitad del siglo XX, la astronomía se basaba exclusivamente en las observaciones de radiación electromagnética (visible). En los años treinta se empezaron a detectar los rayos cósmicos, que son partículas, principalmente protones y partículas alfa. El gran progreso de la astronomía del siglo XX se desarrolló por el uso de dispositivos para "ver" más allá del rango óptico. Observaciones de radiación de alta frecuencia ha sido posible gracias a la puesta en órbita de observatorios espaciales. Por lo tanto, hay una cobertura de un rango que se extiende desde longitud de onda de metros, hacia energías de Mega electrón-volt, en el dominio del los rayos gamma. En un pasado no muy lejano, se pensaba que el origen de los rayos cósmicos estaba relacionado con fenómenos galácticos. Hace algunos años que una componente extra-galáctica ha sido descubierta. Y hay otras partículas elementales que prometen ser una fuente de observación muy importante: los neutrinos cuya interacción con la materia es muy débil, y que por lo tanto necesitan de grandes masas de materia para aislar estas interacciones del efecto de otras. El detector de neutrinos "Icecube" — un kilómetro cúbico de hielo, que busca los neutrinos de las fuentes astrofísicas más activas: estrellas explosivas, explosiones de rayos gamma y fenómenos extremos que involucran agujeros negros y estrellas de neutrones — en el polo sur puede descubrir neutrinos procedentes de más allá del sistema solar. Además, radiación muy, muy, energética, que es producida por procesos nucleares en el átomo, es y será detectada por instrumentos como los telescopios Cerenkov que se están volviendo mucho más sensibles. Y creo que los mayores y más fascinantes descubrimientos vendrán por el desarrollo de la habilidad de detectar las ondas gravitatorias. La primera detección ha sido en el 2015 per el LIGO (Laser Interferometric Gravitational Observatory, en ingles), y un año después, otra detección de ondas gravitatorias ha sido acompañada da una observación obtenida con telescopios ópticos. Eso fue un éxito maravilloso. Hay dos telescopios de ondas gravitatorias en servicio y otros están siendo desarrollados y planeados. La reciente misión espacial LISA pathfinder, como su nombre deja entender, incluye el objetivo de probar algunas tecnologías que deberían ser empleadas por la misión espacial LISA, un interferómetro láser con base en el espacio. Las ondas gravitatorias tienen longitudes de onda extremamente grandes, proporcionales a las dimensiones de los objetos y del sistema gravitatorio que las emiten. Y la intensidad es más alta cuando dos objetos se acercan entre si y se funden en un mismo objeto. Esto puedes pasar con una pareja de estrellas de neutrones, o de agujeros negros. Hasta ahora, las detecciones han sido de un sistema doble de agujeros negros (la primera detección) de masa intermedia (algunas decenas de masas solares), y de estrellas de neutrones. La detección es posible solo en los instantes anteriores a que los objetos se fundan en uno solo (un proceso llamado merging en inglés), ya que la energía emitida es proporcional al inverso de la separación elevada a la cuarta. Pero hay un comportamiento temporal típico que se puede observar bajo un ruido que, hasta ahora, cubre la señal gravitatoria.
Creo que los próximos años verán un increíble desarrollo en la detección de ondas gravitatorias. Hasta ahora hay tres detecciones confirmadas, pero estos procesos de merging se cree que son muy frecuentes en el Universo, y descubrirán objetos que son difícilmente detectados con telescopios ópticos y también con telescopios espaciales operativos en altas energía. Por lo tanto las ondas gravitatorias van a abrir literalmente una nueva ventana hacia el universo. Hoy se habla de astronomía "multimessenger", con múltiplos mensajeros, para enfatizar la diferencia con el pasado, cuando se tenía únicamente la radiación electromagnética para las observaciones astronómicas. Por astronomía multimessenger se entiende la astronomía con neutrinos, con rayos cósmicos, y obviamente con ondas gravitatorias. Y creo que las próximas décadas van a ser extremamente fascinantes por la astronomía multimessenger, pero también por el desarrollo de la técnica interferométrica que permite de superar una de las dificultades más desafiantes que encontré la astronomía óptica desde el principio: la resolución espacial, que es decir el nivel de detalle que se puede obtener con los telescopios. Lo que vamos a ver irá más allá de nuestra imaginación.
Nunca como en estos momentos la astronomía ofrece perspectivas fascinantes para las jóvenes mujeres que intenten acercarse a ella, con una sólida formación en matemáticas y física. Me gustaría mucho volver a ser joven y empezar de nuevo los estudios de astronomía. ¡Sí, quiero ser astrónoma!
Paola Marziani
Doctora en Astrofísica
Investigadora / INAF – Osservatorio Astronomico di Padova
Me preguntan por qué quise ser Astrónoma. ¿Qué es lo que me llevó a estudiar esta hermosa carrera? Voy a la biblioteca de mi casa, y ahí está, destacándose entre todos los libros. Lo tomo entre mis manos y lo vuelvo a ver con la misma alegría y emoción de cuando mi Papá me regaló este libro hace ya más de 30 años... es COSMOS de Carl Sagan. Al repasar sus hojas no puedo evitar escuchar en mi cabeza la música que tenía al comenzar la serie hecha para la televisión. Lo tomo entre mis manos y tarareando, vuelvo frente a mi computadora para escribir sobre porqué soy Astrónoma.
Fue justamente cuando tenía cerca de 10 años que por primera vez vi COSMOS y me dije: "yo quiero ser Astrónoma", y como se imaginarán, es muy extraño que una niña tan pequeña de esa respuesta a quién le pregunta: ¿qué quieres ser cuando seas grande?
Tuve la suerte que mi Familia siempre me alentó a perseguir mis sueños, y que además, en donde vivo, existía la carrera de la Licenciatura en Astronomía. La misma se continúa dictando en la Facultad de Matemática, Astronomía y Física (FaMAF) en la Universidad Nacional de Córdoba, Argentina. Debo decir que cuando, siendo adolescente decía que iría a la FaMAF, la reacción de las personas en general era de señalar que esa era una carrera de locos, que en general iban hombres, que había que ser un genio para ir allí, y que si me recibía, no podría vivir de ello. Y llegó el día, haciendo oídos sordos a esas opiniones de comenzar ese camino, en el cual me hice de amigos que aún conservo.

" ... El Cosmos es todo lo que es, todo lo que fue y todo lo que alguna vez será. La contemplación del cosmos nos conmueve. ...". Carl Sagan. (COSMOS, 1980, Ed. Planeta, 7° edición, comienzo del capítulo primero)
La carrera me costó mucho al principio, porque más allá de lo duro de los contenidos de las materias que veíamos, que fueron principalmente Física y Matemática, yo no tenía una buena base para el primer año, ya que había hecho mis estudios en un colegio comercial. Estudiaba y estudiaba, y a veces los resultados no eran los que yo esperaba, pero como estaba convencida que yo quería ser Astrónoma, me esforzaba más, le buscaba diferentes vueltas a la manera de estudiar, hasta que un día, después de algunos años, llegó el momento de preparar mi tesina para optar al grado de Licenciada en Astronomía.
Los últimos dos años de la Licenciatura se dictan totalmente en el Observatorio Astronómico de la Universidad Nacional de Córdoba, y allí debía elegir algún profesor para que fuera quien me dirigiera en mi tesina. De la misma manera en que estaba convencida que quería ser Astrónoma, también lo estaba de querer ser Astrónoma observacional, y tuve la buena fortuna que, después de varias charlas, el Profesor Juan José Clariá aceptara ser mi director. El tema a investigar fue acerca de los cúmulos estelares tanto de nuestra Galaxia como de las dos galaxias cercanas llamadas Nubes de Magallanes, sobre los que también hice mi doctorado en la FaMAF, y que aún hoy estudio, en compañía de quien fuera mi director y que hoy además es mi amigo. Poder observar esos grupos enormes de estrellas y luego, a partir de esas observaciones, determinar sus propiedades fundamentales, tales como edades, cantidad de polvo, metalicidades, me llena de entusiasmo y de intriga. Conociendo estos objetos, podremos lugar inferir las propiedades e historias de las galaxias a las que pertenecen.
Siempre he trabajado con datos observacionales, que en general yo obtengo. Si bien no puedo olvidar el hechizo que sentí la primera vez que vi un telescopio en serio, el de la Estación Astrofísica de Bosque Alegre (Córdoba, Argentina), mi fascinación continuó en aumento, mientras continuaban creciendo los telescopio con los que iba trabajando: el del Complejo Astronómico el Leoncito (CASLEO, Argentina), los del Observatorio Interamericano de Cerro Tololo (CTIO, Chile), hasta llegar a trabajar con los grandes telescopios. Sí, en efecto, pude lograr el sueño de mi vida como Astrónoma observacional al obtener un puesto de postdoc en el Observatorio Europeo del Sur (ESO), trabajando durante 250 noches con los telescopios UT de más de 8 metros de diámetro en el Observatorio de Cerro Paranal (Chile). Allí, observaba los proyectos observacionales de otros colegas en el "modo servicio", teniendo la oportunidad de observar galaxias tan distantes que ni siquiera eran visibles, pasando por estrellas a punto de estallar, como Eta Carinae, hasta objetos tan cercanos y familiares como el planeta Marte. Mis años allí, fueron inolvidables.
Estando en la ESO tuve, además, la oportunidad de trabajar un año en el Observatorio de Bologna (Italia). En estos dos observatorios tuve la suerte de tener por "jefes" a los Drs. Michael West y Angela Bragaglia, de quienes guardo un hermoso recuerdo.
Y más allá de todos los viajes que pude hacer gracias a mi carrera, en diferentes observatorios y yendo a congresos en diferentes partes del mundo, conociendo lugares y colegas que se convertían en amigos, yo quería volver a mi Córdoba, cerca de mi Familia en Argentina. Hoy en día soy docente en el Observatorio Astronómico y miembro del Consejo Nacional de Investigaciones Científicas y Técnicas (CONICET). Tengo la oportunidad de vivir dignamente siendo Astrónoma, haciendo docencia, investigación, divulgación y también gestión. Respecto a la divulgación de la Astronomía, quisiera resaltar la enorme satisfacción personal que significa ver la fascinación de la gente al presentar una charla, ya sea en una escuela con niños pequeños o en un taller de adultos con personas de edad avanzada. Personalmente, yo creo que, en palabras de Mario Bunge "... es deber de todo profesor de ciencias, de divulgarla extra muros, dentro y fuera de la Universidad, dar conferencias, cursos, en donde fuere...".
En breve, pienso que este es un lugar oportuno para agradecer a Carl Sagan, ya que es por "COSMOS" que soy astrónoma. Fue viendo su serie que de pequeña soñé con estudiar Astronomía. Tuve la suerte que mi Familia me acompañara para concretar mi sueño. Hoy tengo la fortuna de trabajar como astrónoma y vivir de mi profesión. ¿Cuál es mi recomendación? ¡Qué persigas tu sueño! No hay que ser ni genio, ni superdotado, ni estar altamente preparado para hacer la carrera de Astronomía, aunque ciertamente te sería más fácil, sólo tienes que sentarte a estudiar y maravillarte de lo que aprendes. Si tienes la posibilidad de estudiar lo que te gusta, ¡adelante entonces!
Andrea Verónica Ahumada
Doctora en Astronomía
Universidad Nacional de Córdoba, Observatorio Astronómico
Consejo Nacional de Investigaciones Científicas y Técnicas (CONICET)
Argentina
Nunca he tenido un telescopio de aficionado. Mucha gente se extraña cuando le cuento que mi acercamiento a la astronomía no se hizo como el de otros compañeros, que se iniciaron de jóvenes en agrupaciones de astrónomos aficionados, o que tenían en casa un pequeño telescopio con el que escrutar el cielo.
Tampoco -¡y esto extraña aún más!- conozco de memoria las constelaciones. Aparte de las más famosas y evidentes, siempre tengo que consultar para identificarlas un planisferio celeste, o ahora, en esta era digital, cualquier aplicación de móvil de las muchas que te guían por el cielo nocturno. He asistido a algunas observaciones con aficionados que me dan mil vueltas en el conocimiento cartográfico del cielo.
¿Cómo he llegado entonces a ser astrónomo?
Mi interés por la astronomía se gestó primero a través de la lectura.
En casa teníamos las típicas enciclopedias en tomos y en ellas fue donde comencé a leer artículos que describían el cielo, los fenómenos físicos que determinan el brillo de las estrellas, cómo se descubrió la expansión del Universo… A partir de ahí, con mis pequeños ahorros, compré algunos libros, como "El Universo" de Isaac Asimov, o "Los tres primeros minutos de Universo" de Steven Weinberg… Ahora que escribo estas líneas creo que tuve una aproximación "astrofísica", más que "astronómica" a esta apasionante rama de la física.
El espaldarazo definitivo creo que se gestó cuando en televisión emitieron por primera vez la serie "Cosmos" de Carl Sagan (Fig. 1). En aquella época, al comienzo de los años 80, supuso una revolución en el aspecto de la divulgación científica, tanto por los contenidos, como por el carisma del autor.

Fig. 1. Carl Sagan y la portada de su libro “Cosmos” (1980). Este gran divulgador, con su estilo y la potencia de su mensaje, cambió a muchas personas la visión del universo y del propio papel y presencia de la raza humana dentro de él. También inspiró –como fue en mi caso- a una generación de astrónomos que nunca le estaremos lo suficientemente agradecidos. (Crédito: Sakman Hameed, Express Tribune Blogs).
Con unos efectos especiales que hoy cualquier joven consideraría limitados, pero con unos temas profundos, bien hilados, y contados con mucha pasión e inteligencia, creo que no solo a mí, sino a muchos otros compañeros, nos empujó a estudiar astrofísica. A veces, después de una charla divulgativa, los asistentes me piden que les recomiende algún libro para iniciarse… Mi respuesta es invariable: corran y consigan "Cosmos", obviamente no contiene los descubrimientos que se han hecho en los últimos cuarenta años, pero el texto es tan inspirador que al leerlo uno queda atrapado para siempre en este fascinante mundo (como ejemplo leed el capítulo "Quién habla en nombre de la Tierra"...).
Mi camino
Estudié Ciencias Físicas en la Universidad Complutense de Madrid. Me interesaban todos los campos, y aunque al comenzar la carrera estaba abierto a cualquiera de las especialidades, mi prioridad era la astrofísica. En aquellos tiempos la carrera duraba cinco años y era en los dos últimos cursos donde se escogía la especialidad. Cada curso tenía ocho asignaturas cuatrimestrales, todas ellas bastante intensas. Al terminar hice la Tesina de Licenciatura. Algo curioso y que, sorprendentemente, condicionó mi vida científica, ocurrió en aproximadamente 10 segundos. Subí al Departamento de Astrofísica con mi compañero Javier Gorgas, hoy Catedrático en la Universidad. Ambos queríamos hacer la Tesina y nos dijeron que tenían dos posibles temas, uno relacionado con astrofísica extragaláctica y otro con astrofísica estelar; sin pensarlo mucho, Javier comentó "a mí me atraen más las galaxias", y yo dije "pues a mí las estrellas", y así fue. Siempre pienso que si hubiéramos elegido el otro tema, nuestras trayectorias habrían sido completamente diferentes, habríamos trabajado en lugares distintos y colaborado con otros investigadores… en suma, estaríamos en un "Universo paralelo" a este.
Hice la Tesis, también en la Universidad Complutense, bajo la dirección de la Dra. María José Fernández Figueroa, en la caracterización de estrellas binarias con actividad cromosférica; básicamente son binarias cuyas componentes son estrellas parecidas al Sol, pero el hecho de formar parte de un sistema doble acentúa la generación de campos magnéticos y por tanto todos los fenómenos relacionados con ellos. Recuerdo con mucho cariño las noches en las que íbamos a trabajar a lo que entonces era la Estación de Seguimiento de Satélites de la Agencia Espacial Europea (ESA), en Villafranca del Castillo (VILSPA, en el acrónimo con el que se conocía en aquella época). Nos dejaban usar sus medios informáticos porque los del Departamento no eran suficientes para realizar nuestro trabajo… pero a horas intempestivas, para no interferir con el trabajo durante el día. Aquel paisaje con las antenas iluminadas y el entorno internacional fue muy estimulante. A pocos meses de acabar la Tesis, y a través del Dr. Angelo Cassatella, astrónomo en VILSPA, me llegó una posibilidad de trabajo: en el Departamento de Física de la Universidad de Oxford, la Dra. Carole Jordan, una de las especialistas mundiales en el estudio de atmósferas de estrellas de tipo solar, ofrecía un contrato postdoctoral… y allí fui, contratado tres años por la Universidad, y como me sentía cómodo, prolongué mi estancia otros tres años, financiado por una beca del Consejo Superior de Investigaciones Científicas. Fue un periodo estupendo y enriquecedor, aunque he de reconocer que duro en algunos momentos por el hecho de haber tenido que comenzar allí una vida desde cero, en otro ambiente, en otro idioma, y lejos de la familia. Allí conocí al Prof. John H. Thomas, físico solar de la Universidad de Rochester, en Nueva York, con el que colaboré muchos años, y del que hablaré un poco más adelante. Después de mi estancia postdoctoral, volví a España, primero con un contrato de investigador en el Laboratorio de Astrofísica Espacial y Física Fundamental (LAEFF) y posteriormente conseguí una plaza de científico del CSIC en el Instituto de Astrofísica de Andalucía. Actualmente trabajo como investigador en el Centro de Astrobiología.
¿Qué investigo?
Mi carrera siempre se ha centrado en la física estelar. Durante mi tesis me di cuenta de que no solo las estrellas binarias son complicadas, sino que las estrellas, tomadas individualmente, presentan también muchos problemas, de modo que abandoné la "binariedad" y desde entonces me he concentrado en diversos aspectos del Sol y de las estrellas, sobre todo de las de baja masa, por debajo de aproximadamente cinco veces la masa del Sol. He mencionado al Profesor Thomas (Jack) anteriormente. Charlando un rato tomando un café en el Departamento, me propuso que trabajáramos juntos en un problema de física solar, que se conocía desde aproximadamente 1910, pero que no tenía una solución teórica satisfactoria.
>
Fig. 2. Imagen de manchas solares y de la granulación solar. La estructura de la fotosfera solar –el “disco” que observamos- está esculpida por la presencia de campos magnéticos a diversas escalas. Las manchas solares son manifestaciones de campos magnéticos intensos que surgen a través de la zona convectiva del Sol. En esta zona, que abarca el último tercio del radio solar, el transporte de energía se realiza por convección de células de gas. La granulación solar muestra claramente la configuración de esas células convectivas. (Crédito: Telescopio solar de la Academia de Ciencias de Suecia, Observatorio del Roque de los Muchachos).

Fig. 2. Imagen de manchas solares y de la granulación solar. La estructura de la fotosfera solar –el “disco” que observamos- está esculpida por la presencia de campos magnéticos a diversas escalas. Las manchas solares son manifestaciones de campos magnéticos intensos que surgen a través de la zona convectiva del Sol. En esta zona, que abarca el último tercio del radio solar, el transporte de energía se realiza por convección de células de gas. La granulación solar muestra claramente la configuración de esas células convectivas. (Crédito: Telescopio solar de la Academia de Ciencias de Suecia, Observatorio del Roque de los Muchachos).
El fenómeno, conocido como "efecto Evershed" consiste en un flujo de materia en la penumbra de las manchas solares con ciertas características peculiares. Comenzamos estudiando los casos más sencillos, introduciendo en los cálculos más y más complicaciones, y logramos una explicación convincente que publicamos en la revista Nature… es mi única publicación en esa revista y curiosamente, en contra de lo que suele encontrarse en ella, no es un trabajo observacional, sino teórico. Me imagino que el hecho de haber encontrado una solución a un problema que estuvo ahí casi 100 años tuvo su peso. Con Jack y su familia aprendí a hacer esquí acuático en el lago Keuka, donde tenían una pequeña casa… un deporte totalmente "ortogonal" para un astrónomo que viene de las planicies manchegas. Posteriormente he tocado varios "palos". Me ha interesado la evolución estelar, el cálculo de parámetros absolutos de estrellas (temperatura, gravedad, metalicidad). He tenido la suerte de trabajar en equipos internacionales, con todo lo que ello comporta, tanto desde el punto de vista científico como humano, tan importante uno como otro. Una de las colaboraciones más satisfactorias ha sido el proyecto DUst around NEarby Stars (DUNES) coordinado por el Prof. Carlos Eiroa, de la Universidad Autónoma de Madrid, y enfocado a la detección de estructuras análogas al Cinturón de Kuiper de nuestro Sistema Solar, alrededor de estrellas de nuestra vecindad. Usamos datos del Observatorio Espacial Herschel, de ESA, el mayor telescopio espacial nunca puesto en órbita, con su espejo de 3.5 m de diámetro, que será superado cuando el James Webb Space Telescope entre en operación.
Actualmente trabajo en la detección de exocometas alrededor de estrellas de la llamada secuencia principal, es decir, estrellas ya formadas que están quemando hidrógeno de manera estable. Desde 1995 sabemos que existen planetas orbitando en torno a otras estrellas (exoplanetas), y hemos encontrado sistemas planetarios múltiples, como Trappist 1 (siete planetas), o Kepler 90 (ocho planetas), que plantean la incógnita de cómo se forma, en general, un sistema planetario. La presencia de cuerpos menores, como exocometas, es un ingrediente más a ser tenido en cuenta. En los últimos años estamos realizando un estudio sistemático con observaciones que obtenemos desde los observatorios del Roque de los Muchachos, en La Palma, Calar Alto, en Almería, o en Chile. ¡Observar con un telescopio profesional es una experiencia única!
No quiero terminar sin mencionar otra de mis pasiones, la divulgación astronómica. Disfruto mucho impartiendo charlas en colegios, institutos, museos o planetarios. Me divierten, y he participado regularmente en ellos, los programas de radio -no tanto la televisión, las cámaras me intimidan un poco- y creo que, además de ser un placer, es nuestro deber darle a la sociedad lo que ella nos da: nos pagan por pensar y por hacer ciencia básica -que no quiere decir que sea fácil, sino que su primera finalidad es aportar conocimiento- de modo que de una forma u otra hemos de abrirnos para compartir nuestra fascinación por el cosmos.
El futuro es apasionante… el Universo nunca dejará de sorprendernos. Tenedlo siempre en mente.
Benjamín Montesinos Comino
Doctor en Ciencias Físicas
Investigador Científico de Organismos Públicos de Investigación (OPI)
Departamento de Astrofísica, Centro de Astrobiología (CAB, CSIC-INTA)
Para ser astrónomo se necesita una sola noche. En mi caso, fue una noche sin luna en lo alto de la sierra del estado de Guerrero, en México.
Guerrero un estado agreste, extremadamente caluroso, donde hay que hervir la leche dos veces al día para que no se descomponga y donde hay que revisar la cama antes de acostarse para asegurarse de que no hay escorpiones.

Fig. 1. “Los sonidos de la Tierra”. Disco que viaja con las sondas Viajero (2). (Crédito: De NASA - Great Images in NASA Description, Dominio público, https://commons.wikimedia.org/w/index.php?curid=6455682)
Pero también es un estado de espesas selvas, de extensas playas azules y de cielos límpidos. A mis tíos les gustaba recorrer la serranía guerrerense para cazar huilotas (1) y conejos. En las largas vacaciones de los veranos de mi infancia, mi primo y yo pasamos muchas tardes en la caja trasera de una camioneta recorriendo paisajes extraños en la promesa de un lugar donde abundaban las presas. Yo odiaba con todo mi ser la cacería, pero al menos disfrutaba mucho los paseos. Buena cosa que mis familiares casi siempre regresaban con el morral vacío.
Mala cosa que yo siempre regresaba morado de piquetes de insectos.
En una de aquellas frustradas zaleas, nos llegó la noche en un lodoso sembradío de estropajos. Los cazadores intentaban en vano sacar la camioneta de un atasco de barro. Caminamos varios kilómetros para encontrar ayuda. Los serranos solidarios se armaron de maderas y cuerdas para ayudar a sortear el dilema. De camino al lugar del incidente caí por una ladera. Intenté asirme de unas ramas pero estas se rompieron y me resbalé varios metros sobre un terreno plagado de duras raíces. Me laceré fuertemente la espalda, pero no lloré porque sabía que mis primos se reirían y que nadie ahí se conmovería o me consolaría. Por eso me senté esa noche a soportar el dolor al pie de un árbol, y en un momento dado miré hacia arriba.
Siendo yo un pre-púber criado en una gran ciudad, mi contacto con la astronomía se había dado solamente a través de los libros, televisión o películas. El espacio siempre había llamado mi atención, y me emocionaba mucho la voz doblada de Carl Sagan hablando acerca de los planetas que visitaron las sondas Viajero (2), pero el cielo había sido en cierto modo un ente abstracto hasta aquel momento en la sierra. Sin embargo, aquella noche vi por primera vez el fondo negro azabache de la noche y sobre él, un número insondable de estrellas, que parecían a punto de caerme encima. Y recorriendo de un extremo a otro aquel paisaje, la Vía Láctea que solo conocía por los libros, se me reveló entera y grandiosa. Ignoré entonces el dolor de mi espalda, los insectos y el lodo. Ignoré los gritos frustrados de los hombres que tardaron horas en desatascar la rueda. Ignoré desde entonces muchas otras cosas y desde aquel momento me obsesioné con la idea de ser astrónomo.
Ser astrónomo en México, a finales del los años ochenta ya era una posibilidad real, pero a mi alrededor, nadie o casi nadie pudo responder a mis preguntas sobre cómo lograrlo. En la preparatoria mis profesores de primero y segundo año se preocupaban más por mantenernos una hora callados frente al pizarrón que por intentar emocionarnos. No los culpo. Ya entonces las escuelas de bachillerato públicas tenían grupos de cuarenta alumnos, la mayoría de ellos hirviendo de hormonas. Para poder oír algo sobre la ciencia tuve que esperar al tercer año, donde nos separaban en áreas y los grupos eran más reducidos. Mi inquietud era la Física, y la suerte me sonrío con el mejor maestro del mundo. Iracundo y temible, aquel hombre rechoncho escribía sus propios y hermosos textos de divulgación y nos hacía leerlos en voz alta. Gracias a esos textos conocí a Newton y a Kepler, y con ellos en la mano me aventuré a visitar una oscura oficina de orientación vocacional donde el funcionario boquiabierto ante mis preguntas me pidió dos días para averiguar si mi deseo era posible. Cuando regresé me tenía una respuesta: "Necesitas estudiar física", me dijo, mostrándome un listado de cursos con nombres alucinantes. La mayoría requerían matemáticas avanzadas, y yo que odiaba a la profesora de cálculo… pero unos meses después ya estaba aceptado en la Facultad de Ciencias de la UNAM y en el otoño de mi mayoría de edad tomé mis primeras clases.
Para ser astrónomo requerí casi veinte años de estudios, la mitad de ellos fuera de mi país. La carrera duraba nueve semestres, pero aquellos años todos teníamos que hacer una tesis de licenciatura y por eso me tomó cinco años y medio titularme como físico. Los últimos dos tuve contacto constante con el Instituto de Astronomía y disfruté escribir mi tesis -mi primera investigación profesional- como pocas cosas en la vida. Luego pase un año más decidiendo entre quedarme a hacer el posgrado en México o en el extranjero, como la mayoría de mis amigos. Decidí lo segundo. Tarea nada fácil. Migré hacia Estados Unidos, recién casado. Mi esposa y yo éramos dos niños de veinticinco años de edad, y salir del país, rompiendo con ello muchos ciclos familiares fue una epopeya en sí. Pero nos adaptamos, con muchos ánimos y mucha suerte a la vida de estudiante, que tiene muchas carencias pero también muchas alegrías.
Mi disertación doctoral requería de usar una cámara infrarroja muy novedosa. El investigador principal de la cámara, era esposo de mi asesora, una mujer joven y entusiasta. Mi proyecto era emocionante y prometedor. Lo presenté ante un sínodo que me felicitó por mis planes. Pocos meses después llegaron las dificultades con la súbita de muerte del investigador de la cámara por una enfermedad repentina, y con ello mi asesora entristeció muchísimo. Durante mucho tiempo su vida fue complicada y no pudo darnos a sus estudiantes, demasiada atención. Me vi solo, junto a otros estudiantes del proyecto. Durante casi dos años recolectamos y procesamos datos sin saber bien qué hacer con ellos. Aprendí casi todo por mi cuenta, y la lección entonces fue que la ciencia es una lucha personal. Hay mucho que leer, mucho que entender. Mucho. La astronomía requiere de saber física y matemáticas, pero también requiere de entender mucho sobre computadoras, sobre procesamiento de imágenes y sobre gestión de proyectos. Requiere de escribir muy bien, sabiendo cambiar el tono poético por el tono claro y directo de la ciencia. A mí me costó más que a muchos, porque hasta entonces había sido más poeta que astrónomo. También entendí lo que era el estrés y la frustración. A ratos me sentí completamente extraviado y a ratos lo estuve. La ciencia me mostró entonces su otro rostro. El doctorado se piensa como un rite du passage, y vaya que lo fue en mi caso.
La lección más grande en el camino de convertirse en científico es la paciencia. Cualquier licenciatura de ciencia queda incompleta ante la enorme cantidad de conocimiento que se requiere adquirir, y debe extenderse con un posgrado y varios años de posdoctorado que te otorguen la independencia de pensamiento y una línea de investigación original. Conseguir un empleo como científico siempre ha sido difícil porque las plazas son pocas y los solicitantes muchos y todos tan o más buenos que tú. Por eso es que hacerse científico requiere no solamente de buenas notas o de muchas horas en el laboratorio, sino de mucho trabajo personal. Muchos no lo logran. Se requiere a ratos, de mucha fuerza. Hay muchas ocasiones en que sentí que más que vivir, sobreviví la ciencia. Pero al final, lo que importa es haber guardado aquella flama de la adolescencia. Yo guardé siempre la noche oscura de la sierra como un tesoro. La sierra me había marcado mi destino en la espalda, ¿por qué habría de claudicar? El firmamento estrellado fue la brasa con la que volví a encender mi gusto por la ciencia aún en los momentos más complicados. Hoy tengo estudiantes a quienes les intento hacer entender eso.
Hay quienes lo tienen muy claro y atesoran su propio momento, ese en el que decidieron dedicarse a la astronomía.
¡Si tú lo tienes, aférrate a él y no lo sueltes!
Notas (del coordinador):
(1). Más sobre la Huilota Común, http://www.audubon.org/es/guia-de-aves/ave/huilota-comun
Se han mantenido las expresiones originales utilizadas por el autor. El español es una lengua utilizada en multitud de países. Que particularmente no conozcamos una palabra o expresión no quiere decir que esté mal escrita o sea incorrecta. Animo desde aquí a todos los lectores a tener abierta la página de la RAE, http://dle.rae.es/?id=DgIqVCc , e ir consultando las palabras desconocidas siendo conscientes de la variedad y amplitud de nuestra lengua.
(2). En España siempre las conocimos como las Sondas Voyager, https://es.wikipedia.org/wiki/Voyager , http://momentosestelaresdelaciencia.blogspot.com.es/2014/03/carl-sagan_9.html
Carlos Román Zúñiga
Doctor en Ciencias (Ph. D), Especialidad en Astronomía, Investigador
Instituto de Astronomía Universidad Nacional Autónoma de México
Cazador de neu… ¿qué? Alguna vez me había imaginado ser cazador de vampiros, cazador de Pokemon o hasta cazador de quidditch. Pero, ¿cazador de neutrinos? ¿Cómo voy a cazar algo que no sé ni lo que es? ¿Y si luego me muerde?
Entiendo tus dudas. Yo también las tuve. Yo también las tengo todavía. Pero intentemos entenderlo juntos. Te propongo un juego que nos ayudará a entender un poco mejor qué son los neutrinos. Intenta pensar en alguna cosa pequeña, la más pequeña que conozcas. ¿La tienes? ¿Una piedra? Las piedras pueden ser muy grandes… ¡Ah! Te refieres a una piedra pequeña. Muy pequeña. Pero, ¿cómo de pequeña? Por muy pequeña que sea esa piedra siempre habrá otra más pequeña, y luego otra, y luego otra…. Habrá un punto en el que sea tan pequeña que ya dejaremos de llamarla piedra y le daremos otro nombre como el de molécula o átomo. ¿Habías oído hablar de ellos antes? Son muy pequeños, ¿verdad? ¿Sabes lo que hay dentro de los átomos? Partes aún más pequeñas que llamamos partículas. ¿Y dentro de estas partículas? Nada.
Dentro de estas partículas ya no hay otras, al menos que sepamos. Este juego acaba aquí. Si pensaste en estas partículas desde el principio, ganaste. No se conoce nada más pequeño, son las piezas más pequeñas del universo, y por eso se les llama partículas fundamentales o elementales. ¿Por qué estas y no otras? Nadie ha sido capaz de descubrirlo todavía.
Los físicos teóricos en sus despachos y los físicos experimentales en los laboratorios se dedican a investigar estas partículas fundamentales —entre otras muchas cosas, como descubrirás en este libro—. Pasan horas estudiándolas y clasificándolas, como un cazador Pokemon completando su Pokedex, y se han dado cuenta de que existen muchas distintas. Trabajan con partículas como el electrón, los quarks o el bosón de Higgs (si quieres saber qué son estas partículas puedes buscar en otros capítulos de este libro, también en "CIENCIA, Y además lo entiendo!!!" [1]). Todas estas partículas elementales son tan pequeñas que no podemos verlas directamente con los ojos. Ni siquiera con un microscopio normal. Necesitamos los microscopios más potentes del mundo. Máquinas gigantes que hacen chocar partículas muy, muy rápido — por eso se llaman aceleradores de partículas — y en ellos se ponen unas cámaras de fotos muy especiales, diseñadas para detectar cualquier rastro de una partícula que haya pasado por allí — por eso se les llama detectores de partículas —.

Fig. 1. El detector de Super-Kamiokande en Japón cuando estaba siendo rellenado con los 50 millones de litros de agua, mientras científicos en una balsa comprueban las cámaras de fotos con forma de bombilla de las paredes. Imagen del observatorio de Kamioka [2].
Pero hay un tipo de partícula que es muy, muy difícil de atrapar. Si estuviésemos en un partido de quidditch, estas partículas serían tan difíciles de cazar como la snitch dorada. Estas partículas son los neutrinos.
La primera vez que físicos como Pauli o Fermi pensaron que los neutrinos podrían existir se los imaginaron casi como vampiros: eran partículas imposibles de ver, no sabían cómo atraparlas, y si se miraban en el espejo no podían ver su reflejo —en física, esto se conoce como violación de la paridad—. Entonces, pensarás, si no podemos verlos, ¿cómo sabemos si existen? ¡Por eso necesitamos cazarlos!
Esto se consiguió por primera vez en 1956, cuando los físicos Cowan y Reines diseñaron su experimento del neutrino. O dicho de otra forma, diseñaron una trampa para neutrinos.
Prepararon un tanque con agua de manera que si un neutrino era atrapado dentro saltarían chispas, avisando de que había ocurrido, y lo colocaron muy cerca de un reactor nuclear, pues sabían que ahí se producían muchos neutrinos. Pusieron la trampa cerca de la madriguera. ¡Qué listos! Por algo fueron los primeros cazadores de neutrinos de la historia.
Por suerte, los neutrinos no se producen sólo en los reactores. En realidad, ni siquiera necesitamos producirlos nosotros. Se crean en la atmósfera de la Tierra, en el Sol y en todo el universo. Se crean muchos. Muchísimos. Tantos que cada segundo miles de neutrinos atraviesan la Tierra. Qué digo miles, ¡miles de millones! Por lo tanto, lo único que tenemos que hacer es coger un cubo y sentarnos en un parque a esperar a que algún neutrino caiga dentro.
Ay, ojalá fuese tan fácil.
¿Recuerdas que los neutrinos eran tan difíciles de ver como los vampiros? Pues esto es porque son capaces de atravesar casi cualquier cosa sin alterarse, sintiendo apenas un cosquilleo débil. Prácticamente ningún neutrino se enteraría de que estamos allí esperándolos. Con nuestro cubo en el parque, tendríamos suerte si cazásemos un neutrino, sí, sólo uno, en toda nuestra vida.
Pero estoy seguro de que ya habrás visto el problema. El cubo es muy pequeño, ¡necesitamos un cubo más grande! Eso mismo pensaron en Japón, donde construyeron un cubo gigante llamado Super-Kamiokande (Fig. 1.). Lo hicieron bajo una montaña, en una vieja mina, para protegerse de la luz —ves como se parecían a los vampiros — y de otros rayos que vienen del cielo, y lo llenaron de unos 50 millones de litros de agua. ¿Sabes cuánta agua es ésta? Podrías beber 1000 litros de agua al día durante 100 años y aún te sobraría. ¿Te lo imaginas? ¡Te pasarías meando todo el día!

Fig. 2. El sol por la noche visto con neutrinos. Crédito del observatorio de Kamioka [2].
Claro, con un cubo tan grande sí que podremos encontrar neutrinos. Por eso se llaman detectores de neutrinos y los físicos han construido otros parecidos en muchas partes del planeta, ¡incluso bajo el mar o bajo el hielo de la Antártida! Cada vez construyen detectores más grandes y sofisticados, y con ellos cada vez aprendemos más sobre los neutrinos.
¿Te apetece hacer una cosa divertida con los neutrinos? ¡Saquemos una foto al Sol! ¿Qué, que eso lo puedes hacer cualquier día con tu móvil? Vale, hagámoslo más interesante, ¡¡Saquemos una foto al Sol por la noche!! ¿No me crees que se pueda hacer? Pensemos dónde está el Sol por la noche. Exacto, al otro lado de la Tierra, bajo nuestros pies. Su luz no llega hasta nosotros porque no puede atravesar la tierra, por eso la noche es oscura. Pero el Sol también nos manda neutrinos y ellos sí que pueden atravesar la Tierra. Nuestros ojos no pueden ver estos neutrinos, tampoco nuestros móviles, pero los detectores de neutrinos sí. Así que lo único que tenemos que hacer es usar estos detectores gigantes y apuntar hacia abajo. ¡Y ya está! Tenemos una foto del sol por la noche, ¡hecha con neutrinos! (Fig. 2.)
Gracias a estos detectores podemos estudiar los neutrinos. ¿Sabes cuántos neutrinos hay? Por ahora se han encontrado tres tipos distintos. También se ha descubierto que los neutrinos no son siempre del mismo tipo, que les gusta cambiar de estilo. ¡Qué pesados!
Todos estos descubrimientos sobre los neutrinos son difíciles de conseguir, pero muy importantes para la física. Tanto que casi todos han supuesto el premio Nobel para quienes lo consiguieron. Aún nos quedan muchas cosas que aprender sobre ellos, sobre cómo son y cómo se comportan. Es importante seguir investigándolos. Y es que los neutrinos también pueden esconder secretos sobre muchas otras propiedades del universo, incluso de su propio origen. ¿Te parece curioso? ¡A mí también! Por eso me dedico a estudiarlos.
Los neutrinos son unas partículas muy extrañas. El universo está lleno de ellos y aún así nos cuesta mucho verlos y estudiarlos. Es un mundo misterioso que débilmente llegamos a entender, repleto de secretos que se nos escapan. Para resolverlos, tendremos que cazar neutrinos. ¿Te atreves?
Referencias:
[1] A.M. Uranga Urteaga, Capítulo 46 y V. Martín Lozano, Capítulo 47 del Libro "CIENCIA, y además lo entiendo!!!" (Ed.: Q. Garrido Garrido):
[2] Observatorio de neutrinos de Super-Kamiokande: http://www-sk.icrr.u-tokyo.ac.jp/sk/index-e.html
Xabier Marcano
Doctor en Física Teórica
Investigador postdoctoral en el Laboratoire de Physique Théorique de Orsay, Francia.
Cuando era pequeña, para intentar asimilar el entorno y entenderlo, mi curiosidad se encarnaba en la pregunta "¿por qué?". Con los años la curiosidad se arropó con un poco de discernimiento y la pregunta evolucionó naturalmente a "¿cómo?", pues llegar a conocer el cómo es realmente lo que lleva a entender en profundidad.
Perseguir el cómo te hace pensar, elucubrar, intentar encajar la información que vas obteniendo y hacerte una idea, tener una hipótesis. Cuando llegas a la hipótesis vas a comprobarla. A veces aciertas, a veces no. Si aciertas, hay chispitas en el cerebro y la sonrisa, por dentro y por fuera, te calienta un rato y sigues caminando.
Ese, a grandes rasgos, sería mi proceso general cuando me pongo a intentar entender un cómo cualquiera. Pero lo que a mí me gusta son los materiales. ¿Por qué precisamente estudiar y entender los materiales? La respuesta práctica y fácil es que es algo útil y con lo que se puede encontrar trabajo con relativa facilidad. Mi respuesta es que, además y sobre todo, me gusta intentar llegar al cómo de las cosas que puedo, generalmente, tocar. Me gusta ser capaz de pasear y disfrutar sabiendo, o intentando deducir, qué hay detrás de la elección de determinados materiales que tengo a mi alrededor.
Los materiales tienen propiedades. Aquello que se puede medir, cuantificar y, con suerte, cambiar para adaptar el material a la aplicación que persigues. Lo más interesante es buscar y entender qué hace que un material sea especial con respecto a otro y cómo hacer que un material sea especial. Hay propiedades para todos los gustos, electromagnéticas, ópticas, mecánicas, térmicas, acústicas, químicas… La conquista de estas propiedades se hace estudiando cómo puedes influir en ellas modificando, por ejemplo, distintas variables en el procesado del material, como temperatura o presión, o añadiendo aditivos que te proporcionen color, resistencia a la fractura o biodegradabilidad. Entender la interacción entre materiales y sus propiedades y procesado lleva a la evolución y a la aparición de materiales nuevos. Las lentillas blandas son ahora muchísimo más cómodas que hace veinte años porque progresivamente su formulación ha aumentado su permeabilidad al oxígeno y su capacidad para absorber agua añadiendo materiales con un porcentaje en agua mayor (más hidrofílicos). También son más baratas porque a alguien se le ocurrió que era posible moldearlas en la misma cavidad cóncava en la que vienen empaquetadas.
Comprender las propiedades te lleva, a veces, las menos, a poder usarlas o, simplemente, las más, a poder abandonarte al asombro. Porque hay materiales que se calientan al ordenarse (estirad una goma marrón vulgar y apoyadla en los labios para notar el aumento de la temperatura). Porque el color azul de las alas de las mariposas proviene no de un pigmento, como la mayoría de los colores, si no de la interacción de la luz con la estructura nanométrica del polvo que tienen sobre ellas. En realidad, ese polvo son escamas distribuidas periódicamente que provocan un efecto de interferencia en la luz que hace que se reflejen azules brillantes.
Una herramienta muy útil para orientarse con las propiedades son los diagramas de fases, que resumen de forma gráfica cómo cambia un material de fase al variar las condiciones en las que se encuentra. El diagrama de fases más conocido es el de presión y temperatura del agua, que indica cómo, variando esas dos magnitudes, cambiamos de agua en fase sólida, a líquida o gaseosa. Menos conocido es el diagrama de fases hierro-carbono, fundamental en metalurgia, que permite navegar por el acero. Aún menos conocido es el del jabón, donde hay una fase, formada por empaquetamientos muy compactos de columnas en geometría hexagonal, que resulta tan viscosa que hay que evitarla a toda costa a la hora de fabricarlo porque puede paralizar la producción. Y hay uno que debiera ser conocido por todos, y no solo por las fábricas, para evitar muchas frustraciones, que es el de la mayonesa. Aplicaciones mil, e insospechadas, de los diagramas de fases.
Además de las propiedades en el estudio de materiales, también son fabulosas las herramientas con las que se puede trabajar para obtener información. Porque con una muestra de un material en la mano, con los sentidos, aunque se pueden deducir bastantes cosas, no se puede extraer todo lo que nos permiten las variadas técnicas experimentales que se han ido desarrollando a lo largo del tiempo. Una cosa es que te hablen de átomos y otra cosa es ver, literalmente, los átomos, bien colocaditos como en una huevera, con un microscopio de fuerza atómica. O ver qué pinta tiene un helado: su estructura de cristales de hielo, grasa, azúcar y burbujas de aire, usando un microscopio electrónico de barrido. Puedes trabajar con espectroscopías que te informan de la energía de los enlaces, la disposición de unas estructuras moleculares con respecto a otras y su interacción, ¡cómo están conformadas las proteínas! Puedes trabajar con reómetros que te indican cómo reacciona un fluido al ser agitado, la relación entre movimiento y su viscosidad. Experimento reológico casero: el yogur, que es tixotrópico, va a disminuir su viscosidad con el movimiento de cizalla, dadle a la cuchara y veréis. Puedes trabajar con calorimetría diferencial de barrido que calienta una muestra y puedes observar las transiciones de fase de un polímero, viendo a qué temperatura el polímero cambia de propiedades. La más importante, la temperatura de transición vítrea, indica cuándo pasa a régimen cristalino, estado más frágil, y explica la catástrofe del Challenger en 1986.
Pensar en materiales no es solo pensar en los sospechosos habituales como el trozo de metal o el trozo de plástico. Es pensar en la madera, que tiene distinta elasticidad según la dirección de la deformación, para las mesas y para las tablas de snowboard. Es pensar en la pintura de las paredes que es una emulsión a la que hay que ajustar la tensión superficial para que moje la pared adecuadamente. En las lociones corporales con estudiada viscosidad para que resulte agradable extenderlas sobre la piel. En la espuma de afeitar, (¿cuán grandes tienen que ser las burbujas de aire para que sea cómoda de aplicar y tenga buena consistencia?) En cartón o en papel (una estructura hexagonal de papel o cartón es extremadamente resistente a la deformación longitudinal). En los zafiros y las impurezas en su estructura cristalina que les dan los diferentes y preciosos colores. Es pensar en la leche, en las fibras de las telas, en los esmaltes de uñas, en la saliva, en la cerámica de las baldosas, en la fibra de vidrio de los aviones, en la fibra óptica que hace que el mundo ahora mismo sea como es. Es pensar en un huevo y sus múltiples posibilidades (eso sí que es un material en condiciones: tortilla, huevo frito, huevo duro, pasado por agua, ¡merengue!).
Por la noche, cuando ya no hay luz que ilumine el material a analizar y se acaba la diversión, miro las estrellas. E imagino lo que está pasando en ellas, porque sé que hay presión y hay temperatura y hay electrones y protones moviéndose y luchando por ponerse de acuerdo, átomos decidiendo cómo colocarse para crear material. Materiales. Pensar en eso también, entonces, me hace sonreír.
Conchi Pulido de Torres
Máster en Ciencia y Tecnología de Polímeros (Universidades de Aston y Birmingham)
Doctora en Física de Materiales: "Dispositivos fotónicos de medida basados en fibra óptica de polímero (UAH)"
Recuerdo el día en que hablé con mi padre sobre el espinoso tema de cuáles serían mis estudios universitarios. Hasta entonces había pasado por varias fases: estudiar magisterio, o incluso filología inglesa (que en mi caso habría sido una opción fácil, teniendo madre inglesa). Con todo el respeto hacia esas opciones, lo cierto es que ninguna de las dos me convencía demasiado. Siempre me había sentido atraído por las ciencias, pero nunca me había planteado seriamente la posibilidad de estudiar una carrera científica, y mucho menos dedicarme profesionalmente a la ciencia (que al fin y al cabo es para lo que se supone que uno estudia una carrera). Pero, ya en el último año de mis estudios pre-universitarios, era hora de tomar una decisión en firme. La primera parte de esa decisión consistió en desechar opciones por las que no sintiese un mínimo de entusiasmo, así que el magisterio y la filología quedaron descartados. La segunda fue reducir el rango de opciones: decidí que estudiaría una carrera científica, a elegir entre física o química. Mi padre se alegró enormemente con esa decisión, y así me lo dijo aquel día.
Ahora sólo era cuestión de tomar una decisión final: ¿física o química? ¡No era tan fácil! Yo me inclinaba más por la física, pero en aquellos tiempos, en mi ciudad, Alicante, no era posible estudiar esa carrera, aunque sí había licenciatura de química. Estudiar física suponía realizar mis estudios en otra ciudad, con la consiguiente carga económica para mi familia (en aquellos tiempos no había muchas becas), y todas las complicaciones añadidas que se derivan de dejar el nido familiar. Con esos condicionantes, no es extraño que al final triunfara la opción de estudiar química; no obstante siempre me ha quedado la curiosidad por saber cómo me habrían ido las cosas si hubiese optado por estudiar física.
Así pues, con una decisión ya tomada, me embarqué en mis estudios de química con entusiasmo, y para mi agradable sorpresa descubrí que la química y la física tenían en común más de lo que yo había supuesto. De hecho, se estudiaba mucha física en la licenciatura de química, además de matemáticas, y por supuesto, química. Varias de las asignaturas del temario tenían el nombre de química-física. Estas asignaturas eran invariablemente las que me gustaban más, y me resultaba cómico descubrir que a mis compañeros de estudios en general no les sucedía lo mismo; ellos sí tenían claro que lo suyo era la química, y no la física. Mi preferencia por las asignaturas más tendentes a la física acabó valiéndome el sobrenombre de "el anti-químico". No es que yo renegara de la química, ni mucho menos, pero el mote me hacía gracia.
Acabado el tercer curso de la carrera de ciencias químicas, que en aquellos tiempos constaba de cinco, se me planteó una nueva disyuntiva: podía seguir como hasta entonces y acabar la carrera en la Universidad de Alicante, o bien podía marcharme para completar el segundo ciclo en otra universidad. Quedarme en Alicante suponía acabar con la licenciatura en Química General, ya que allí no existía la posibilidad de cursar ninguna especialidad. Por otro lado, si me marchaba a una universidad más grande, podría especializarme en alguna rama de las que me atraían más, léase química-física o química cuántica. Tres años antes la idea de marcharme se me había hecho muy cuesta arriba, pero la verdad es que ahora me moría de ganas por dejar el hogar familiar y lanzarme a la aventura. Tras cursar asignaturas de química analítica, ingeniería química y otras similares, tenía claro que prefería ahondar en la química-física. Así pues decidí liarme la manta a la cabeza y trasladarme a Madrid para estudiar la especialidad de química cuántica en la Universidad Autónoma, la especialidad más teórica de la química, y por tanto la más cercana a la física.
Después de esos años en Madrid acabé la carrera estudiando más física y más matemáticas que química propiamente dicha, pero disfrutando mucho en el proceso. Después de eso vino la posibilidad de realizar un doctorado en simulación de materiales, en Londres, y así fue como mi inquietud entre la química y la física fue labrando mi carrera científica. Mi doctorado me sirvió para introducirme en el fascinante mundo de la informática aplicada a la investigación científica; me sirvió también para encauzar mi carrera científica en la dirección de la ciencia de materiales, un campo a medio camino entre la física y la química, al que pareciera que me encontraba predestinado sin yo saberlo. Hoy en día trabajo para el Consejo Superior de Investigaciones Científicas, concretamente en el Instituto de Ciencia de Materiales de Madrid, y mi trabajo consiste en emplear técnicas de simulación aplicadas al estudio de propiedades y diseño de nuevos materiales.
¿Qué es la Simulación de Materiales?
Actualmente, a pesar de que nuestro conocimiento de las leyes que gobiernan el comportamiento de la materia a escala atómica y molecular es todavía parcial, resulta posible simular con ayuda de un ordenador muchos materiales de manera suficientemente realista como para poder predecir sus propiedades físicas y químicas. Dichas propiedades son el resultado de las interacciones entre los átomos o moléculas que conforman el material en cuestión. Por ejemplo, si los enlaces químicos entre los átomos son fuertes, como ocurre en el caso del carbono, tendremos un material con alta resistencia a la deformación, un material de gran dureza. Éste es el caso del diamante. Si podemos modelar con suficiente precisión y fidelidad las interacciones que tienen lugar entre átomos y moléculas, podremos calcular cómo dichas interacciones se traducen en propiedades macroscópicas de los materiales resultantes. Todo ello nos puede ayudar a diseñar nuevos materiales con propiedades deseables desde un punto de vista de posibles aplicaciones tecnológicas.
La simulación de materiales también es útil como complemento a la labor experimental. Aunque las técnicas experimentales son cada día más finas y precisas, no siempre resulta posible obtener una visión detallada de lo que ocurre durante un experimento a escala atómica. Sin dicha imagen resulta complicado, cuando no imposible, interpretar certeramente los resultados experimentales. Por ello es cada vez más frecuente que se publiquen artículos científicos en los que se combinan técnicas experimentales y simulación para lograr una interpretación lo más completa posible del fenómeno estudiado.
Gracias a la simulación resulta posible investigar el comportamiento y las propiedades de materiales en condiciones extremas de presión y/o temperatura, condiciones en las que la experimentación resultaría extremadamente difícil y costosa. Preguntas tales como ¿cómo se comportan los minerales que se encuentran en las profundidades del interior de la Tierra, o en el interior de Júpiter o Saturno? resultan muy difíciles de responder mediante experimentos, pero se pueden plantear, y responder al menos parcialmente, mediante simulaciones. Veamos un ejemplo: sabemos, gracias a medidas sismológicas, que el interior de la Tierra se estructura en capas. La capa más externa, sobre la que vivimos, es la corteza; esta se encuentra sobre el manto, que alcanza una profundidad de unos 2900 km, formado principalmente por silicatos, y que a su vez se divide en dos capas, el manto externo y el interno, con una zona de transición entre ambos. Más abajo aún está el núcleo, que nuevamente se divide en núcleo externo e interno. El núcleo se compone principalmente de hierro. En el núcleo externo el metal se encuentra en estado líquido, mientras que en el núcleo interno es sólido. Las medidas sismológicas nos informan además sobre la presión y sobre la densidad a medida que aumenta la profundidad; sin embargo, no nos dicen nada acerca de la temperatura. Una forma de deducir indirectamente la temperatura a la que se encuentra el interior de la Tierra a la profundidad a la que se encuentra la transición entre el núcleo interno y el externo (unos 5100 km) es medir la temperatura de fusión del hierro a 330 GPa (3,300,000 atm), la presión a la que se da esa transición. Dichos experimentos son extremadamente costosos y difíciles, y durante mucho tiempo no han sido concluyentes, ya que distintos grupos han obtenido resultados divergentes. Sin embargo, para una simulación las altas presiones no son a priori un problema. Hace ya algunos años, un grupo de geofísicos empleó técnicas de simulación ab initio para predecir que el hierro a 330 GPa de presión funde a la pasmosa temperatura de 6000 K, una temperatura comparable a la que impera en la superficie del sol. Por lo tanto, esa debe de ser la temperatura a la que se encuentra la frontera entre el núcleo interno y el externo. Posteriormente, esta predicción ha sido corroborada experimentalmente en varios estudios.
Hoy en día la simulación se emplea asiduamente en la mayoría de las disciplinas científicas, desde la física y la química a la biología, o, como acabamos de ver, la geología. Yo he encontrado mi línea de trabajo en este fascinante mundo de la simulación aplicada al campo de la investigación en ciencia de materiales. Es un campo que me ha dado un sinnúmero de satisfacciones, tanto personales como profesionales.
Eduardo Hernández
Doctor en Ciencias, Especialista en Simulación de Materiales
Investigador Científico del CSIC en el Instituto de Ciencias de Materiales de Madrid
Alguna vez te has preguntado ¿por qué hay vida en la Tierra y no en otros planetas? ¿Cómo se originó la vida? ¿Fueron los asteroides los que trajeron agua y vida a la Tierra? ¿O es el Sol el responsable de la vida?

Fig. 1. a) Foto de un cráter y varios cañones en Marte tomada por la sonda Mars Express. b) Plutón visto por la sonda New Horizons. c) Foto de la superficie de la luna Titán tomada por la sonda Huygens. d) Foto del hemisferio norte de Saturno y sus anillos tomada por la sonda Cassini. e) Foto de Cassini de los geiseres de agua de la luna Encelado.
Alguna vez has pensado ¿hay vida más allá de nuestro planeta? Y si esto fuera así, ¿cómo podríamos encontrarla? ¿Cuáles son las condiciones para que exista la vida? Alguna vez has sentido curiosidad por saber ¿por qué la Luna afecta a los océanos? ¿Por qué la Luna siempre nos muestra su misma cara? ¿Por qué otros planetas tienen más lunas que la Tierra? ¿Hay océanos y volcanes más allá de la Tierra? ¿Cómo un sistema planetario evoluciona? Alguna vez te has preguntado ¿cómo se formó el Sistema Solar y cómo funciona? ¿Cómo el Sol influye en los planetas? ¿Está el espacio vacío o está lleno de material procedente del Sol? ¿Alguna vez has te has sentido fascinado por las auroras boreales? Has querido saber ¿qué son y cómo se originan? ¿De dónde vienen las partículas energéticas que nos dan esas bellas luces celestes cerca de los polos terrestres? ¿Qué información nos dan sobre nuestro propio planeta y sobre el Sol? ¿Ocurren también en otros planetas?
Pero sobre todo, alguna vez te has preguntado ¿cuáles son las grandes preguntas que la ciencia planetaria trata de resolver?, y ¿cómo la exploración espacial es su principal herramienta? Yo sí, miles de veces. Y también todos los científicos planetarios se hacen estas y muchísimas más preguntas día tras día, e investigan para encontrar una respuesta. Si tienes curiosidad, alma científica, te gusta el espacio y admiras la naturaleza, este es tu sitio.
¿Qué es la ciencia planetaria y para qué sirve?
La ciencia planetaria es la disciplina que se encarga de buscar respuestas a preguntas básicas tales como cómo se forman los planetas, cómo funcionan, y por qué al menos la Tierra contiene vida. Para ello, se encarga del estudio de los planetas y de sus sistemas planetarios desde el punto de vista científico, incluyendo el estudio de sus lunas, sistemas de anillos, nubes de gases, y magnetosferas. Puede parecer una definición complicada, pero básicamente viene a decir, que los científicos planetarios nos encargamos de entender cómo los sistemas planetarios se forman, cómo se organizan y evolucionan en el tiempo, y cómo todos sus componentes interaccionan entre ellos. Es una disciplina en la que todos los campos de la ciencia son bienvenidos, como la física, la química, la astronomía, las ciencias atmosféricas, la geología, la geodesia, la biología, etc. En mi caso particular, mi especialidad es la física del plasma espacial. Esta motivación ha inspirado una serie épica de 50 años de viajes exploratorios a través de naves espaciales que han visitado casi todo tipo de cuerpo planetarios en nuestro vecindario espacial.
¿Cómo se da respuesta a todas estas preguntas?
Los científicos planetarios usamos numerosas técnicas diferentes, que engloban numerosas ramas de la ciencia. Por ejemplo, mandamos naves no tripuladas a otros planetas para obtener datos de todo tipo, como datos atmosféricos, químicos, geológicos o magnéticos. Todas las imágenes de la Fig. 1 fueron tomadas por este método. También usamos grandes telescopios para hacer observaciones de planetas y lunas distantes, o de cometas. Estos telescopios se encuentran tanto en las montañas más altas de la Tierra (por ejemplo, en Hawái, los Andes o el Teide en las islas Canarias), como en el espacio (por ejemplo, el telescopio espacial Hubble). Todas las imágenes de la Fig. 2 fueron tomadas desde el espacio por el telescopio Hubble. En algunos casos, hacemos experimentos en laboratorios o en diferentes lugares de la Tierra que puedan replicar diferentes condiciones planetarias. Por ejemplo, Rio Tinto en Huelva es un excelente análogo marciano, puesto que sirve para reproducir las condiciones de acidez extremas encontradas en la superficie de Marte. Todos los datos obtenidos de cualquiera de las maneras anteriormente expuestas, son analizados por nosotros en nuestros ordenadores con programas específicos y comparados con modelos teóricos que previamente fueron desarrollados.

Fig. 2. a) Imagen de la aurora de Júpiter. b) Foto del cometa Siding Spring (C/2013 A1) a su paso por Marte. Ambas imágenes fueron tomadas por el telescopio espacial Hubble.
En muchos casos, estos datos permiten crear modelos nuevos del campo particular de estudio.
Un caso concreto: La exploración de Marte
Uno de los principales cuerpos del Sistema Solar que ha sido y está siendo estudiado en profundidad, es Marte. Muy probablemente, la respuesta a la pregunta sobre si hay o ha habido vida en el Sistema Solar, se podría encontrar allí. Marte pudo tener las condiciones óptimas (especialmente en su temprana historia) donde se piensa se pudieron originar componentes prebióticos, que son los causantes de la vida en la Tierra entre otros. A lo largo de la historia, Marte ha sufrido cambios colosales en las condiciones de su superficie, donde todo indica que antes hubo océanos. Estos cambios fueron producidos por los bruscos cambios de temperatura (cambios climáticos) a lo largo de su órbita alrededor del Sol (la órbita de Marte es muy elíptica), y también por cambios en la radiación solar que llegaba a Marte y gases de efecto invernadero. Gracias a esta evolución, los científicos planetarios pensamos que Marte puede conservar casi intactos los signos de procesos prebióticos, que hace mucho desaparecieron en la Tierra. Por lo tanto, si encontrásemos estos signos, Marte sería un laboratorio real en el que poder observar y entender cómo la vida se abrió camino en la Tierra. Esto es esencial para nosotros puesto que la evolución geológica, química y biológica van de la mano.
La exploración de Marte y la posibilidad de que allí hubiera vida, han captado desde siempre la atención de la humanidad, pero no fue hasta 1960 cuando la URSS lanzó la primera misión con destino a este planeta, la Marsnik-1. Desde entonces, casi 50 misiones (y 6 en construcción para ser enviadas en los próximos años) han tenido el mismo objetivo: profundizar en los conocimientos de nuestro vecino y entender la evolución que lo ha llevado a su estado actual.
Hoy por hoy, hay ocho misiones activas en el entorno de Marte:
- La sonda Mars Odyssey de la NASA (agencia espacial americana) lanzada en 2001
- La sonda Mars Express de la ESA (agencia espacial europea) lanzada en 2003
- El vehículo robótico Opportunity de la NASA en la superficie de Marte lanzado en 2003
- La sonda Mars Reconnaissance Orbiter de la NASA lanzada en 2005
- El vehículo robótico Mars Science Laboratory ("Curiosity") de la NASA lanzado en 2011
- La sonda MAVEN de la NASA lanzada en 2013
- La sonda MOM de la India lanzada también en 2013
- La sonda ExoMars TGO de la ESA lanzada en 2016
Un poco de mi investigación…. ¿Está perdiendo Marte atmósfera en el espacio?
Estudiar el espacio se puede hacer desde muchas perspectivas, como la astronomía y la astrofísica. Pero a mí lo que de verdad me gustaba era la exploración de los planetas, el poder mandar robots o personas a otros lugares del espacio. Por eso me decidí a estudiar Física, y en concreto, hice la especialidad y Máster de Geofísica y Meteorología. Con esta formación hice mi Doctorado sobre la ionosfera de Marte. Y, ¿qué es la ionosfera? Pues la ionosfera es la capa más alta de la atmosfera de un planeta, luna o asteroide, que como su nombre indica, se encuentra en una larga proporción formada por iones, es decir, en el estado de plasma (que es el cuarto estado de la materia). Estos iones se producen gracias a la radiación solar, en concreto a la radiación en el extremo ultravioleta y en rayos-X, que al ser muy energética, es capaz de ionizar las moléculas de la atmosfera más alta y formar iones. Como la ionosfera es un plasma formado de muchísimos iones y también electrones, es un medio conductor. Esto quiere decir que la física que describe su comportamiento, sigue las leyes de los campos eléctricos y magnéticos.
Marte a diferencia de la Tierra, no tiene un campo magnético global que proteja al planeta.

Fig. 3. Representación de la tormenta solar gigante que llegó a Marte en Septiembre de 2017. Las líneas blancas representan el campo magnético interplanetario y las partículas de color naranja-rojizo el viento solar. El arco blanquecino alrededor de Marte representa el “choque de arco” que es producido por el impacto del viento solar con la alta atmósfera. El cuadrado inferior contiene observaciones de Mars Express de este evento, donde se aprecia un incremento de más de dos órdenes de magnitud en las partículas registradas por la nave.
Este campo magnético en la Tierra hace que nuestra atmosfera quede protegida dentro de una cavidad que se llama "magnetosfera". Sin embargo, en el caso de Marte, la ionosfera se encuentra en contacto directo con el "viento solar". Es bueno indicar que el medio interplanetario no está vacío, sino que está lleno de partículas de alta energía procedentes del Sol que se conocen como viento solar. A su vez, existe un campo magnético interplanetario que se expande por todo el Sistema Solar y procede del Sol. La magnitud del campo magnético interplanetario suele ser relativamente pequeña, unos 5 nT en Marte, aunque en caso de una tormenta solar como la de la Fig. 3, esta magnitud aumenta muy notablemente. Por tanto, la ionosfera de Marte se encuentra en contacto directo con el viento solar y con su campo magnético, lo que hace que se produzca un choque supersónico entre el plasma procedente del Sol y el plasma de la ionosfera de Marte, que se manifiesta en forma de arco como se ve en la Fig. 3. Mi trabajo consiste en estudiar este choque, que dependiendo de si llega una tormenta solar a Marte o no, puede ser muy intenso. Como consecuencia fundamental, la atmosfera de Marte se está erosionando y perdiendo en el espacio. Esta es una de las principales razones por la que la atmosfera de Marte es muy delgada en la actualidad y hace a su vez, que el planeta sea tan árido.
Para concluir…
Miles de lugares exóticos y únicos os están esperando para que los exploréis y para que ayudéis a dar respuestas a las grandes preguntas que aun a día de hoy no se han podido resolver. La exploración y la ciencia planetaria van siempre de la mano y todo lo que nos pueden aportar tanto a nivel personal, en forma de una carrera científica, como a nivel colectivo, en forma de descubrimientos, avances en tecnología, etc., son excepcionales. Si te gusta la ciencia y el espacio, ¡éste es tu sitio!
Y por supuesto, nunca debéis olvidar que como dijo Isaac Newton (1643-1727): "Si he visto más lejos es porque estoy sentado sobre los hombros de gigantes".
Beatriz Sanchez-Cano
Doctora en Ciencias Físicas
Post-Doctoral Research Associate, University of Leicester, Reino Unido.
Uno de pequeño no sabe qué es la cosmología, pero sí sabe mirar al cielo y ver las estrellas. Así fue como terminé haciendo un doctorado en cosmología, mirando estrellas. Desde pequeña mi madre me llevaba de noche a ver la lluvia de estrellas del 15 de agosto, las perseidas. Pasábamos los veranos en un pequeño pueblo de León y allí el cielo es precioso. Siempre me preguntaba ¿qué eran las estrellas?, ¿dónde estaban?, ¿cómo se movían?, ¿qué había más allá?... Así que estudié Física y después terminé especializándome en cosmología, que es la ciencia que estudia el Universo.
Podemos decir que todos (sí, tú también) llevamos un físico dentro, todos nos hacemos preguntas acerca del mundo que nos rodea. Todos los que habéis mirado alguna vez al cielo y os habéis hecho preguntas, además de físicos sois cosmólogos. La cosmología es una de las ciencias más antiguas; ya los griegos, los chinos y los egipcios hace miles de años se preguntaban cómo era el Universo. Durante años la cosmología se ha limitado a ser una ciencia principalmente teórica. Sin embargo, con el desarrollo de la tecnología hemos pasado de ver unas pocas galaxias en placas fotográficas hace 50 años, a tener hoy en día cámaras muy potentes en grandes telescopios que toman imágenes de millones de galaxias en pocos minutos.
Vivimos una época dorada de la cosmología con un gran número de observaciones de cada vez mayor precisión. Es a través de las observaciones como podemos contrastar las teorías y modelos que se han hecho durante siglos sobre el Universo. Hay telescopios en Tierra y en órbita. Los que están en el espacio tienen la ventaja de no tener atmósfera que distorsione sus observaciones, de no depender del tiempo, y de poder observar durante todo el día. Su inconveniente es que son muy caros y si algo se estropea no es fácil de arreglar.
El descubrimiento de la materia oscura y la energía oscura en el siglo XX ha supuesto una revolución en cosmología. La naturaleza de estos dos componentes del Universo es uno de los grandes retos de la cosmología hoy en día. Desconocemos el origen del 95% del contenido energético del Universo, al 5% que conocemos (la materia de la que nosotros estamos formados, lo que forma los planetas, las estrellas y las galaxias) es lo que llamamos materia bariónica. Las observaciones nos dicen que el ~26% del Universo es materia oscura, un tipo de materia que no vemos pero que sabemos que está ahí por sus efectos gravitatorios. Y por último, el ~69% del Universo es energía oscura, un tipo de energía que desconocemos y hace que el Universo se esté expandiendo aceleradamente.

Las observaciones del Universo han llevado a establecer el modelo estándar de la cosmología, llamado ΛCDM por sus siglas ’Cold Dark Matter’ o ’Materia Oscura Fría’; y Λ por la energía oscura, cuyo modelo más simple es una constante cosmológica. Hoy en día grandes colaboraciones formadas por cientos de científicos toman datos para seguir comprobando el modelo estándar a grandes y pequeñas escalas, e intentar averiguar la naturaleza de la materia oscura y la energía oscura. Las principales observaciones para ello hoy en día son:
- El fondo cósmico de microondas (Cosmic Microwave Background, CMB). En el origen del Universo todo era una sopa de partículas muy caliente (todas las partículas chocaban continuamente unas con otras). Con el tiempo esta sopa de partículas se fue expandiendo y haciendo cada vez más grande. Esta sopa estaba formada por fotones (partículas que forman la luz y no tienen masa) y lo que los cosmólogos llamamos bariones (partículas que tienen masa y van más despacio que la velocidad de la luz). Al expandirse el Universo, se enfría la sopa de partículas y llega un momento en que los fotones ya no chocan apenas con los bariones, y decimos que se desacoplan. Cuando el Universo tenía unos 380.000 años los fotones se separan de los bariones y viajan libremente por el Universo. Viajan hasta hoy en día que podemos detectarlos en todas direcciones con grandes telescopios de microondas. Primero COBE, después WMAP y hoy en día Planck han sido los satélites principales encargados de estas observaciones.
- Las supernovas de tipo Ia. Las supernovas son explosiones estelares, en particular las de tipo Ia se producen cuando una enana blanca (estadío final de una estrella como el Sol) está en un sistema binario con otra estrella de la que acreta materia hasta explotar. Una sola supernova puede llegar a brillar tanto como una galaxia entera. Se utilizan para medir distancias. Gracias a este tipo de supernovas se descubrió la expansión acelerada del Universo, con la publicación de los resultados de los proyectos ‘Supernova Cosmology Project’ y ‘High-z Supernova Search Team’ en 1998.
- Las lentes gravitacionales. Se forman cuando un objeto masivo (lente) curva la luz que viene de un objeto que se sitúa detrás suyo (fuente) en nuestra línea de visión. La forma y luminosidad de la fuente se ven distorsionadas por la lente. Existen distintos tipos de lentes gravitacionales que pueden utilizarse para encontrar planetas extrasolares, detectar objetos muy masivos que no emiten luz como agujeros negros, y también para estudiar la energía oscura y la materia oscura.
- Las oscilaciones acústicas de bariones. En el Universo primitivo, bariones y fotones se comportaban como un único fluido. La atracción gravitatoria de los bariones se contrarrestaba con la presión de radiación de los fotones creando ondas de presión, lo que se denominan oscilaciones acústicas de los bariones (BAO). Cuando los fotones se desacoplan, estas oscilaciones se ‘congelan’ y puede verse su huella en la distribución de galaxias y en el CMB. Se observaron por primera vez en la distribución de galaxias en 2005 por la colaboración SDSS ‘Sloan Digital Sky Survey’.
- Los cúmulos de galaxias. Son las estructuras más grandes observadas en el Universo. Podemos medir su distancia y ver cómo ha cambiado su densidad a lo largo de la historia del Universo. Por lo tanto, podemos utilizarlos para averiguar más cosas sobre la historia de la expansión del Universo.
Las ondas gravitacionales y la detección directa e indirecta de materia oscura también son importantes observaciones cosmológicas que se están llevando a cabo hoy en día, pero haría falta otro capítulo para hablar de ello.
Yo trabajaba en la colaboración internacional ‘Dark Energy Survey’. Esta colaboración fue creada para descubrirla naturaleza de la energía oscura y ha construido una potente cámara digital de 570 Megapixeles, DECam, instalada en el telescopio Blanco de 4 metros en Cerro Tololo en Chile. Lo que tiene de especial DES es que combina cuatro maneras diferentes de estudiar la energía oscura: supernovas de tipo Ia, oscilaciones acústicas de bariones, cúmulos de galaxias y lentes gravitacionales.
Durante mi doctorado lo que hice fue desarrollar un método para medir el bias con datos del ‘Dark0 Energy Survey’.

La relación entre la distribución de galaxias y la de materia oscura es a lo que llamamos bias de las galaxias. Lo que observamos con un telescopio son galaxias, no materia oscura, ya que esta no emite luz. Las galaxias se forman en los halos de materia oscura, y por lo tanto trazan la distribución de materia oscura. Es como si quisiéramos saber dónde están los continentes en la Tierra mirando una imagen del planeta de Noche. Entender la relación entre galaxias y materia oscura es esencial para calcular los parámetros del modelo estándar y conocer la distribución real de materia en el Universo.
Ana Isabel Salvador Junco
Doctora en Cosmología
Actualmente viajo por el mundo divulgando ciencia, puedes seguir mis aventuras en: http://acogeauncientifico.com/
Al terminar el doctorado me di cuenta de que me gustaba más hablar de mi investigación que realmente hacerla, por eso quiero dedicarme a la divulgación y la docencia.
Cosmólogo es aquel que estudia el Universo como un todo. Como eso es inabarcable, uno tiene que romperlo en pedacitos de tiempo y espacio, y estudiar cada parte por separado. Hay cosmólogos que estudian el universo primitivo, desde el origen del Universo y el proceso inflacionario que dio el pistoletazo de salida, hasta aproximadamente un segundo de vida, cuando se formaron los primeros elementos.
Estos investigadores suelen tener una formación de físicos de partículas y les interesan los procesos que tienen lugar en los aceleradores como el Gran Colisionador de Hadrones del CERN. Otros estudian el universo tardío, desde un segundo hasta hoy en día, trece mil ochocientos millones de años más tarde. Estos investigadores suelen tener una formación de astrofísicos y les interesan las explosiones de supernovas, la formación de galaxias, la materia oscura y la expansión acelerada del universo, usando telescopios muy potentes en altas montañas o en órbita alrededor de la Tierra.
Naturalmente, el Universo es más que la suma de sus partes, luego lo ideal para un cosmólogo es formarse tanto como físico de partículas relativista como astrofísico, pues muchas veces las respuestas a las preguntas fundamentales sobre el Universo están tan imbricadas que tanto uno como otro se quedan cortos. Esta formación lleva tiempo, mucha paciencia y mucho tesón, pero la recompensa en inmensa pues no hay nada más maravilloso como ser capaz de comprender fenómenos que abarcan sesenta órdenes de magnitud en tiempo y espacio, que involucran todas las fuerzas de la naturaleza y requieren del conocimiento profundo de las herramientas más poderosas que tiene el físico: la relatividad general, la mecánica cuántica y la termodinámica.
Yo he tenido la suerte de conocer a algunos de los cosmólogos más famosos de la segunda mitad del siglo XX, como Stephen Hawking, Jim Peebles, Rashid Sunyaev, Joe Silk, Igor Novikov, Alan Guth, Andrei Linde, Alexander Dolgov, Kip Thorne, etc. Todos ellos se caracterizan por tener una visión particular del universo, a veces muy distintas unas de otras, pero, al fin y al cabo, consistentes. Es difícil encontrar un denominador común a todos ellos, excepto quizá su enorme curiosidad y su infatigable ansia de comprender fenómenos muy alejados de nuestra experiencia cotidiana, donde es necesario usar la imaginación y una visión espacial y temporal muy amplia.
Es por eso que es difícil aconsejar a un(a) investigador(a) joven qué camino tomar para ser un(a) cosmólog(a) profesional. En mi caso, recuerdo muy bien con catorce años leer el libro de Asimov "El Universo" y quedarme fascinado con lo que allí se describía. Cuando entré en la universidad estaba convencido de que quería ser astrofísico, pero pronto me di cuenta de que necesitaba una formación más teórica si quería entender el origen del universo, de manera que me formé como físico de partículas, pasé temporadas en el CERN, hice la tesis en teoría de cuerdas, y me fui de postdoc a Stanford con Andrei Linde, a trabajar en la teoría inflacionaria. A la vuelta a Europa me di cuenta de que necesitaba conocer de primera mano las observaciones que se estaban haciendo en el fondo cósmico de microondas, en la formación de galaxias y en la expansión acelerada del universo. Fueron años en los que la Cosmología pasó de ser una ciencia fundamentalmente especulativa a una ciencia experimental.
Desde 2005 empecé a formar parte de colaboraciones científicas como el Dark Energy Survey, el Physics of the Accelerating Universe Survey, el consorcio Euclid de la ESA, el Cosmic Origins Explorer, el Large Synoptic Survey Telescope y, más recientemente, el detector de ondas gravitacionales en el espacio, Laser Interferometer Space Antenna. La perspectiva que da comprender cómo se obtienen los datos, cómo se limpian de errores sistemáticos y finalmente cómo se interpretan en el contexto de las últimas teorías físicas, es algo que me emociona profundamente y que justifica con creces los esfuerzos, las pequeñas frustraciones y sinsabores que toda profesión tiene.
Por ello, animo fuertemente a los jóvenes a participar intensamente en la aventura del saber que es comprender el universo, desde lo más pequeño a lo más grande.
Juan García-Bellido Capdevila
Doctor Física Teórica
Profesor de la Universidad Autónoma de Madrid
Dicen que los adolescentes solo escuchan a dos personas: a sus ídolos musicales y a su profesor de bachillerato. Es una forma —en mi opinión, bastante acertada— de exponer la gran influencia que puede llegar a tener un buen (o un mal) profesor sobre la carrera de sus alumnos; más aún, incluso, que su entorno familiar más cercano.
En mi caso particular, debo admitir que Juan Carlos (mi profesor de física) tuvo muchísimo que ver con que yo quisiera ser físico: hasta entonces, yo tenía clarísimo que quería ser… bueno, la verdad es que tampoco lo tenía demasiado claro. Por un lado, los ordenadores me han apasionado desde muy pequeño (en mi casa todavía hay quien me llama «el botones»), y he sabido desde siempre que quería hacer algo que involucrase trabajar con ordenadores; por otro lado, empecé a militar en política relativamente joven —a los 14—, y quería hacer algo relacionado con legislación (ya sean ciencias políticas, derecho, o alguna carrera del estilo). La entrada de Juan Carlos en escena, en última instancia, hizo que me interesara más por las leyes naturales que por las emanadas de cualquier parlamento.
Y así fue como, tras dos años de bachillerato, al final acabé matriculándome en la Facultad de Física de la Complutense, en Madrid. Me gustaría decir que fui un estudiante ejemplar, pero tengo que reconocer que falté a muchas más clases de las que estoy dispuesto a admitir en público, especialmente en los últimos años. Solo iba a aquellas en las que consideraba que mi tiempo estaba mejor invertido yendo a clase que estudiando el temario por mi cuenta: de esta forma terminaba disfrutando de todas las asignaturas —tanto de las clases magistrales de los buenos profesores como de pelearme con los conceptos de las materias que estudiaba en la biblioteca. Además, también conseguía así evitar el efecto desmotivador de muchas clases (¿alguien dijo "Álgebra Lineal"?).
También, al hacerlo de esta forma, encontré un patrón interesante en mi conducta: mientras que evitaba todo lo posible asignaturas relacionadas con astrofísica y me escaqueaba de muchas de física nuclear, siempre asistía a asignaturas relacionadas con física computacional, electrónica y óptica. Tanto es así que el último año de carrera estuve buscando sitios donde hacer un doctorado en (al menos) una de estas tres áreas. Se ve que tuve suerte, porque tras buscar un poco acabé en un programa de Máster (y de doctorado después) en Fotónica, un área que involucra estas tres áreas de la Física a la vez. En mi opinión, es precisamente esta vertiente multidisciplinar la que le da a la Fotónica un toque especialmente interesante, sobre todo al compararla con otras ramas de investigación similares (como la Óptica, por ejemplo). Más que una investigación fundamental sobre las propiedades de la luz, en Fotónica también es crítico investigar cómo manipularla, y emplear esos conocimientos en otras ramas del conocimiento: de ahí, la aparición de distintas disciplinas dentro de la Fotónica como pueden serla Optoelectrónica, la Física del Láser, la Física de Fibras Ópticas, la Computación Cuántica, la Biofotónica, la Óptica Cuántica o la Nanofotónica.
Podría intentar describir cada una de estas ramas con un cierto detalle, pero temo tanto no ser capaz de hacerles justicia a ninguna como irritar al editor al pasarme del límite de páginas del capítulo. De todas formas, no resulta demasiado difícil de verla influencia de muchas de estas disciplinas en las tecnologías actuales más avanzadas. Por poner un solo ejemplo de cada una: el desarrollo de paneles solares está fuertemente influenciado por los últimos avances en optoelectrónica, siempre buscando arañarle un poco más de energía a la luz solar; la aparición de láseres ultrarrápidos permite a los químicos estudiar reacciones moleculares en tiempo real, incluso con miles de átomos simultáneamente; los avances en fibras ópticas cada vez permiten transmitir más y más información (y sostener, por tanto, más y más conexiones a Netflix); la entrada en escena de los ordenadores cuánticos prometen cambiar radicalmente la informática tal y como la conocemos; por último, la Fotónica también ha influido en la aparición de nuevas terapias contra el cáncer, algunas de las cuales emplean la luz para destruir células tumorales.
Todos estos ejemplos, a su vez, descansan sobre los estudios y avances en las ramas más fundamentales de la Fotónica: la Óptica Cuántica (comprender cómo se comporta la luz cuando no se puede estudiar como un campo electromagnético clásico) y la Nanofotónica (estudiar la interacción entre luz y materia en escalas muy, muy pequeñas) extienden nuestro conocimiento de la luz más allá de los confines de la Óptica Clásica, y nos permiten «ver» los componentes más básicos, fundamentales y diminutos de la materia ordinaria. Bueno, y de la no tan ordinaria: el conocimiento en profundidad de la interacción luz-materia ha permitido la aparición de la disciplina de los simuladores cuánticos: sistemas físicos configurados de tal forma que simulan el comportamiento de otros, los cuales son prácticamente imposibles de estudiar de otra forma (como, por ejemplo, las interacciones dentro de los núcleos atómicos).
Cualquiera de estos temas, a título personal, me resulta increíblemente interesante. Además, todos ellos son auténticos retos, y eso es importantísimo: es complicado mantener la motivación y las ganas de hacer física si no supone un desafío. Sin embargo, que sea un reto es a la vez un arma de doble filo: no todo el monte es orégano, que diría mi abuela. Los periodos de frustración existen: da igual que lleves haciendo física cuatro meses (en una estancia de verano), cuatro años (como yo), o cuatro décadas (como he podido observar en algunos profesores); es necesario capear la frustración, de una forma o de otra, y no es sencillo. De todas formas, estas etapas se pasan, los retos se superan, y la sensación de logro que queda es única y casi irremplazable.
En resumen, lo único que le puedo aconsejar a alguien que esté valorando hacer ciencia es «elige la rama que te motive». Yo lo hice, y a día de hoy estoy más motivado que nunca a continuar.
José Ramón Martínez Saavedra
Doctorando en Fotónica
ICFO-Institut de Ciències Fotòniques, Barcelona
¿Perdón?
¿Exploradora del vacío?
¿Cómo que del vacío?
¿Quieres ser astronauta o algo parecido?
Esas son las preguntas que me hubiera hecho yo, hace unos años, si hubiera leído un título tan raro como este. Probablemente hubiese pensado que quien lo había escrito debía de ser algún flipado intentando captar mi atención. Y lo malo es que lo habría conseguido. ¿Sabes por qué? Precisamente porque me habría picado la curiosidad con esas preguntas, y sería incapaz de no buscarles respuesta. De haber leído ese título tan raro, y haberme planteado tantas preguntas, me habría puesto a leer como loca el capítulo para intentar entender a qué se refería el autor con 'explorar el vacío'. Al sumergirme en las páginas del libro me habría enterado de que quien lo escribió no pretendía ser un astronauta, sino un físico teórico dispuesto a interrogar a una partícula fundamental y a desvelar sus secretos. Me refiero al bosón de Higgs.
Pero, ¿qué es una partícula fundamental? y ¿qué es el bosón de Higgs? Y ya puestos… ¿qué es el vacío? ¡Vaya!, ¡más preguntas!… pues nada, tendré que ponerme a buscar la respuesta.
Con una tontería como leer un día un libro que me llevó a hacerme preguntas, terminé metida de cabeza en la universidad estudiando física. Y tiene gracia, porque después de terminar mi primer año de carrera se descubrió el bosón de Higgs, cuyas propiedades y naturaleza terminaría estudiando años más tarde (aunque, por supuesto, yo entonces no lo sabía). Pasaron los años entre horas y horas en la universidad, física por todas partes y sobre todo, muchas risas. Tuve la suerte de conocer a la mejor gente que hay ahora mismo en mi vida, y que fueron capaces de guiarme y de motivarme a lo largo de una época llena de dudas sobre el futuro. Y así llegué al último año de carrera, en el que por fin descubrí lo que era una partícula elemental y ¡lo que era el bosón de Higgs! Pero claro, descubrirlo no es lo mismo que entenderlo.

Fig. 1: La mecánica cuántica puede parecer muy extraña a veces, pero también puede resultar muy divertida.
Después de terminar la carrera seguía con muchas preguntas en la cabeza, así que decidí seguir adelante en la búsqueda de respuestas. Un Máster en Física Teórica más tarde, empecé el doctorado en el que ahora investigo para descubrir las propiedades y la esencia del bosón de Higgs... ¡Me había convertido en Exploradora del Vacío!Y aun así sé que todavía no entiendo ni la mitad de lo que la naturaleza quiere decirme. Pero esa es la gracia, ¿no? Que siempre haya una pregunta para poder seguir buscando una respuesta. Y te aseguro que la sensación al encontrar esa respuesta no puede compararse con nada, aunque después surjan mil preguntas más. Pero bueno, después de haberte soltado todo el rollo de cómo llegué a dedicarme a esta profesión tan peculiar, la de 'explorar del vacío', ha llegado el momento de contarte qué narices es el vacío, y sobre todo, cómo se explora. Vamos allá.
La verdad es que te he engañado un poco, porque el vacío del que llevo hablando ya una página no es el que se nos vendría a todos a la cabeza. El concepto de vacío que aprendemos en el cole es el de un espacio en el que no hay nada, que está libre de materia. Yo, por ejemplo, me lo imagino como un lugar completamente blanco, sin nada dentro. Pero yo no te he estado hablando de este vacío; del que yo quería hablarte es del vacío cuántico. El vacío cuántico es el estado de mínima energía de un sistema (cuántico), y nos interesa porque sabemos que el universo es más bien perezoso, y siempre tiende a la menor energía posible. Supongo que ahora mismo que te diga que el vacío cuántico es importante no te dice gran cosa, tranquilo, es normal. Para entender su relevancia hay que aprender un par de cosas primero, como por ejemplo, ¿qué significa que sea cuántico?

Fig. 2: Las partículas elementales son las piezas de Lego del universo… y también el pegamento que las mantiene unidas.
A principios del siglo XX, los físicos se dieron cuenta de que las leyes que ellos creían que regían la naturaleza dejaban de funcionar bien cuando intentaban aplicarlas a escalas muy pequeñas, tan pequeñas como un átomo. Por ello tuvieron que desarrollar nuevas leyes que les permitieran explicar el comportamiento de estos objetos muy pequeños. Esas nuevas leyes se llamaron mecánica cuántica, y son una de las rayadas más grandes que la ciencia se haya inventado nunca, pero... funcionan. Nos permiten explicar sucesos que hemos comprobado experimentalmente cuando investigamos en distancias muy pequeñitas, y nos permiten describir de forma correcta el comportamiento de las partículas elementales.
De ahí llegamos a nuestra siguiente pregunta, ¿qué es una partícula elemental? No sé si alguna vez te has preguntado de qué estás hecho, y de qué está hecho todo lo que te rodea. Quizá hayas empezado por algo más simple, y te hayas preguntado de qué está hecha una cosa concreta. Si lo has hecho, probablemente hayas terminado desmontándola, o cargándotela, para averiguar qué tenía dentro, y hayas descubierto que estaba hecha de cosas más pequeñas. Bueno, pues cuando llegamos a algo que ya no podemos cargarnos más lo llamamos partícula elemental. Los físicos llamamos a nuestras "piezas de Lego" —aquellas que no están hechas de nada más pequeño y que nos sirven para construir todo lo que vemos— partículas elementales o fundamentales. Y son unos bichos muy interesantes. Resulta que cuando te pones a mirarlas más en detalle, te das cuenta de que las partículas no son sólo las piezas de Lego, ¡sino que también son el pegamento que las mantiene unidas! Una de las cosas que nos dice la cuántica es que las partículas tienen dos caras, que pueden comportarse o bien como partículas, como cuerpos, o bien como ondas, dependiendo de sus circunstancias.
Entonces, si nos ponemos a pensar en una onda que conozcamos, como la luz, ¿quiere esto decir que de nuestras bombillas salen partículas? ¡Pues claro! La luz es una onda electromagnética y su otra cara —su partícula asociada— es el fotón.

Fig. 3: El Modelo Estándar de la física de partículas.
Esto quiere decir, que, gracias a la cuántica, podemos entender la fuerza electromagnética a través del intercambio de fotones. Por ejemplo, sabemos que las cargas iguales se repelen debido a la fuerza eléctrica. O, dicho de otra forma, si dos electrones que van viajando por ahí cruzan sus caminos, se intercambiarán un fotón, cambiando sus trayectorias y repeliéndose. No suena tan raro así contado, ¿verdad? Todo este asunto de entender qué son las partículas fundamentales y cómo se hablan entre ellas llevó muchos años de investigaciones y experimentos. Después de muchos quebraderos de cabeza, los físicos de mediados del siglo XX consiguieron formular una de las teorías más precisas de la historia de la ciencia: el Modelo Estándar. Esta teoría nos dice cuántos tipos de partículas fundamentales hay, cómo se clasifican y cómo hablan entre ellas.
Pero la teoría tenía algunas pegas. Se conocían bastantes partículas gracias a los experimentos, y la mayoría de ellas tenían masa, pero, ¿de dónde la sacaban? Además, algunas de las partículas que transmitían las fuerzas tenían masa cuando, en principio, la teoría se lo prohibía. ¿Qué estaba pasando? Lo que estaba pasando es que faltaba una pieza del puzle. Faltaba por añadir una partícula a la lista del Modelo Estándar: el bosón de Higgs. El bosón de Higgs (el Higgs para los amigos) es la partícula que nos permite explicar las masas de (casi) todas las partículas elementales que conocemos a día de hoy. También resuelve el problema de por qué algunas partículas que pensábamos que no debían tener masa sí que la tenían. Así, este bosón llegó como el salvador del Modelo Estándar, completándolo al fin.
Pero no estaba todo hecho, ni mucho menos. En ciencia, las teorías, las ideas, hay que probarlas. Y la cosa es que, por muy bonito que fuera el bosón de Higgs, hasta ese momento sólo era una idea que "tenía" que ser verdad para que todo funcionara, pero que nunca nadie había visto en un experimento. ¿Por qué? Porque las teorías no predecían sus propiedades. Nadie sabía cuál tenía que ser su masa ni cuáles tenían que ser sus características principales, así que era muy difícil de encontrar, simplemente porque no se sabía dónde buscar.

Fig. 4: El bosón de Higgs, salvador del Modelo Estándar.
Sin embargo, después de casi 50 años, por fin se encontró al Higgs en el LHC, el Gran Colisionador de Hadrones, un cacharro enorme con forma de rosquilla que, básicamente, acelera dos partículas a muchísima energía y las hace chocar entre sí para que nos cuenten sus secretos y propiedades.

Fig. 5: Colisión de partículas en el LHC en la que se ha producido un bosón de Higgs.
Así se terminó de completar el Modelo Estándar, y se consiguieron medir la masa y las propiedades de esta escurridiza partícula. Pero a día de hoy nadie entiende por qué el Higgs es como es. Y a esto me dedico yo, a inventarme explicaciones de por qué el Higgs es tal y como lo hemos visto en el LHC, y a predecir cuáles serían las consecuencias que ello tendría. Así, si en el futuro se mide alguna de estas consecuencias, sabré que mis invenciones eran ciertas.
¿Y qué tiene que ver todo esto con el vacío del que hablábamos al principio? Resulta que el hecho de que el Higgs fuera capaz de explicar las masas de las partículas, y de arreglar las otras pegas que tenía el Modelo Estándar, viene de su comportamiento en... el vacío cuántico. Por eso, al investigar las propiedades del bosón de Higgs, ¡me convertí en exploradora del vacío!
Como veis, explorar el vacío poco tiene que ver con ser astronauta, ¿o sí que tiene que ver? Esa es una pregunta que tendréis que intentar responder vosotros, igual que las que os hayan surgido al leer este capítulo. Preguntando, leyendo, escuchando… Al final la ciencia no es más que eso, usar los conocimientos que tienes, o que tiene otra gente, para intentar encontrar las respuestas a las preguntas que nos hacemos sobre cómo funciona lo que nos rodea. Si alguna vez lo habéis hecho, ya habéis sido científicos. Y si alguna vez habéis encontrado alguna respuesta, ya sabéis lo que se siente. No dejéis escapar la oportunidad de seguir sintiéndolo.
Claudia García García
Estudiante de Doctorado en Física Teórica
Universidad Autónoma de Madrid e Instituto de Física Teórica UAM/CSIC
Desde niño sentí la necesidad de entender la realidad que me rodeaba, de buscar respuestas y desvelar "misterios". Algunas tardes, con la complicidad de mis primos, abríamos armarios y cajones para encontrar cartas y fotos que nos permitían reconstruir historias familiares. Con los textos, las imágenes y algunas preguntas a los mayores de la casa, podíamos recrear en nuestras mentes las peripecias de parientes en ultramar. A veces, fuimos incluso capaces de predecir con gran acierto los regalos que nos iban a traer los reyes magos de oriente… Este "amor por saber", este deseo de abrir cajones para ver lo que hay oculto en su interior, ha permanecido conmigo siempre. Sin duda alguna, me siento heredero de los antiguos filósofos griegos, quienes, hace más de 2500 años, trataban de comprender de forma racional la naturaleza, al ser humano y al Universo en el que habita. Aquí, vamos a hablar de esta última faceta de la filosofía, es decir, del cosmos en general y de mi interés en algunos de sus enigmas.
El Universo en la historia
En la antigua Grecia surgió un movimiento imparable que pretendía entender y describir propiedades, causas y efectos de fenómenos naturales. Comenzaban a brotar las distintas ciencias, basadas en un número muy limitado de experimentos y observaciones, y por lo tanto, plenas de hipótesis, conjeturas y diferentes teorías. Por aquel entonces, incluso nuestra casa común, la Tierra, tenía una forma desconocida. Para algunos era plana (Tales de Mileto), y para otros cilíndrica (Anaximandro) o esférica (Aristóteles). Tuvieron que pasar muchos siglos para zanjar el tema (expediciones de Magallanes y Juan Sebastián Elcano circunnavegando nuestro planeta), y varios más para obtener una confirmación definitiva.

Fig. 1. Grabado Flammarion (1888) mostrando un viajero que alcanza los confines de una Tierra plana, junto a una imagen de la Tierra tomada por el Apolo 17 en 1972. (Créditos: NASA).
Los avances científico-tecnológicos del siglo XX nos permitieron finalmente visualizar la Tierra desde su exterior y ver la gran bola achatada en la que vivimos. En este último experimento, se resuelve una vieja disputa filosófica mediante un método sencillo: observar, analizar los datos y extraer conclusiones. Dicho método científico, o si se prefiere, herramienta filosófica, no solo nos ayuda a descubrir los apasionantes secretos del cosmos, sino también en la toma de decisiones personales. En otras palabras, podemos abordar racional y exitosamente muchos asuntos cotidianos a través del proceso trifásico que consiste en ver, juzgar y actuar en consecuencia. El trabajo científico no está alejado del resto de nuestras vivencias, y puede ser una gran fuente de inspiración a lo largo de nuestra existencia. La ciencia en occidente avanzó lentamente durante los dos primeros milenios, dándonos pocas respuestas a las grandes preguntas sobre el Universo. Sin embargo, tras el final de la era oscura, la dilatada "etapa de armarios cerrados", llegó el Renacimiento. En los siglos XV, XVI y XVII se produce un detrimento paulatino de los mitos y dogmas religiosos, en favor de la investigación y el debate de ideas… ¡comienza la segunda revolución científica! Copérnico propone que la Tierra tiene tres tipos de movimiento, los planetas orbitan alrededor del Sol y la distancia Tierra-Sol es pequeña comparada con la distancia a las estrellas, mientras que Galileo construye los primeros telescopios ópticos de uso científico, al tiempo que descubre los satélites de Júpiter (corroborando el modelo heliocéntrico propuesto por Copérnico) y muestra la existencia de cúmulos de estrellas. Las observaciones sistemáticas del astrónomo Tycho Brahe fueron también una pieza clave para que Kepler formulase las tres leyes que rigen el movimiento de los planetas. Kepler no pudo explicar dicho movimiento mediante un modelo de órbitas circulares, y tras varios intentos, finalmente comprobó que las observaciones eran consistentes con órbitas elípticas. Pero, ¿por qué giran los planetas alrededor del Sol?, ¿son arrastrados por un fluido invisible? Las leyes de Kepler fueron posteriormente usadas por Isaac Newton para construir su ley de gravitación universal, formulando matemáticamente la idea de una atracción entre dos masas distantes, y así, eliminando la necesidad de un fluido impulsor. Newton también estableció las leyes de la dinámica, y participó en el desarrollo del cálculo diferencial e integral. Esta breve historia de la segunda revolución científica (léase también filosófica), nos da pistas sobre los pilares en los que debe sustentarse el avance del conocimiento. Aparte de adoptar un espíritu crítico, abierto y constructivo, es fundamental la realización de nuevos experimentos y observaciones, el desarrollo y uso de nuevas tecnologías (así como de métodos de análisis e interpretación de datos), el acceso a resultados previos y la colaboración entre investigadores.
Filosofía moderna: el Universo hoy
Tras la tercera revolución científica (durante los siglos XIX y XX, y los años trascurridos del siglo actual), hemos construido la filosofía moderna, sustentada en gran medida en la llamada física moderna (estudio y aplicaciones de la mecánica cuántica y la teoría de la relatividad). Esta disciplina, que surgió en los albores del siglo XX de la mano de Max Planck y Albert Einstein, ha servido para avanzar de forma espectacular en nuestro conocimiento del cosmos. Por ejemplo, nos permite comprender la generación de energía en el corazón de las estrellas, la formación de agujeros negros, la enorme producción de energía en discos gaseosos y chorros de partículas ultra-relativistas en núcleos de galaxias o la expansión del Universo detectada por Edwin Hubble. Adicionalmente, la física cuántica también está detrás de la instrumentación más avanzada para estudiar los astros en diferentes regiones espectrales, y de los ordenadores usados para el almacenaje y análisis de datos. Mi fascinación por "lo que hay ahí fuera" comenzó a los 12 años, cuando la vieja televisión en blanco y negro mostraba a dos hombres caminando sobre la superficie de la Luna. Aún recuerdo la hilaridad y el escepticismo que provocó aquel acontecimiento histórico en la segunda mitad del siglo XX. Un abanico de reacciones, que iban desde el entusiasmo más efusivo hasta la incredulidad de muchos mayores, seguramente incapaces de asimilar la tremenda transformación tecnológica que habían vivido. A los 17 años me matriculé en el primer curso de la licenciatura de ciencias físicas, y poco a poco, me fui "enamorando" de la física moderna. Algo más tarde, en paralelo a la gran eclosión de la astronomía en España, emprendí un largo camino por el campo de la astronomía y la astrofísica. Tuve que decidir en qué armarios quería trabajar y que cajones trataría de abrir, y la ambición me llevó hacia los sistemas lente gravitatoria. En dichos sistemas, la luz que emite un núcleo galáctico activo y muy lejano es desviada por el campo gravitatorio de una galaxia masiva situada entre la fuente luminosa y la Tierra. La galaxia que interviene actúa como una lente gravitatoria (efecto relativista), produciendo varias imágenes del núcleo distante. El estudio de estos objetos cósmicos nos informa sobre la estructura de los núcleos activos, cuya maquinaria central es muy probablemente un agujero negro supermasivo.

Fig. 2. Imagen óptica del sistema lente “Cruz de Einstein”. El campo gravitatorio de una galaxia cercana (galaxia lente en rojo) produce cuatro imágenes de un mismo núcleo galáctico distante (imágenes A-D formando una cruz).
También nos revela las propiedades de los halos de materia oscura en las galaxias actuando como lentes, así como del Universo como un todo. Cada sistema es un 3 en 1, ¡un armario con tres atractivos cajones por abrir! A pesar de los impresionantes avances durante los últimos años, aún quedan muchos misterios por resolver. Los esfuerzos de Galileo, Descartes y Newton tratando de resolver el rompecabezas final del sistema solar (¿fluido invisible?, ¿acción a distancia?), se repiten actualmente con dos nuevos puzles fascinantes, en los cuales están involucrados los sistemas lente gravitatoria. El primero se refiere al origen de los movimientos del gas y las estrellas en galaxias, así como de las desviaciones de los rayos de luz que cruzan los halos galácticos. La masa en gas y estrellas no puede explicar dichos movimientos y desviaciones, y la mayor parte de la comunidad científica piensa que existe un halo invisible (oscuro) de materia adicional. Se trataría de una materia exótica, que todavía no ha sido detectada a través de experimentos complejos. En nuestra galaxia, la Vía Láctea, esta componente exótica que no está formada por átomos, se comportaría como un gas isotermo. Este escenario de gas isotermo también funciona en otras galaxias distantes con diferentes morfologías. Sin embargo, algunos investigadores sugieren que no es necesario invocar la existencia de materia oscura en galaxias, ya que las observaciones pueden explicarse mediante una gravedad modificada. Es decir, la ley de gravitación de Newton pudiera no funcionar a grandes distancias (a escalas galácticas), y con correcciones adecuadas, sería posible explicar los movimientos de la materia y las desviaciones de la luz. Un punto débil de esta solución al problema, es que probablemente se requiere una modificación diferente en diferentes galaxias, y así, leyes físicas que dependen del laboratorio considerado. El otro gran tema de debate es la causa de la expansión acelerada del Universo, descubierta por Saul Perlmutter, Brian Schmidt y Adam Riess mediante la observación de supernovas distantes. Este hallazgo supuso el Premio Nobel de 2011 para los tres astrónomos, y abrió un cajón con algunas sombras. Aunque previamente se suponía que la expansión inicial de las galaxias se deceleraba progresivamente como consecuencia de la gravedad, los nuevos resultados apuntaban hacia ingredientes que no se habían tenido en cuenta. Surge así la idea de una energía oscura que sería responsable de la aceleración observada. Pero este escenario también tiene un competidor, ya que algunos astrofísicos piensan que las inhomogeneidades cósmicas (agujeros y cúmulos de materia) pueden explicar la expansión acelerada.
Te toca a ti
Recientemente, se han publicado estudios sobre la evolución de los seres vivos, que explican por qué la especie humana evoluciona tan dramáticamente, mientras que las otras especies animales no lo hacen.
La idea es simple: un gato especialmente "inteligente" puede aprender muchas cosas durante su vida, pero no es capaz de transmitir ese conocimiento adquirido a las siguientes generaciones de su especie. De este modo, cada generación posterior comienza desde cero, sin ningún legado como punto de partida. Sin embargo, la especie humana ha roto esa maldición de repetir y redescubrir mediante el estudio y el aprendizaje en edades tempranas. Así, te toca a ti resolver los problemas abiertos de la filosofía moderna, abrir cajones inexplorados, emocionarte con el nuevo conocimiento, y transmitirle a las generaciones venideras para que no se rompa nunca la cadena y se alcance la utopía de una sociedad basada en la razón, la paz y el conocimiento.
Luis J. Goicoechea
Doctor en Ciencias Físicas
Catedrático de Astronomía y Astrofísica, Universidad de Cantabria
¿Y cómo no iba a querer serlo? Cuando uno tiene curiosidad por todo lo que le rodea y le gusta tocar, abrir, probar, hurgar, romper, experimentar con todo cachivache que se pone a su alcance… tiene muchas papeletas para acabar haciendo una carrera de ciencias. Y si además los cuerpos animados, especialmente los viscosos, te producen cierta repulsión, ¡bienvenido! Vas a acabar en el mundo de las matemáticas, la física, la química o las ingenierías.
Puede que, sin saberlo, ya desde pequeño quisieras ser físico. En mi caso, ya desde niña andaba buscando respuestas a preguntas, cuando menos, ambiciosas: ¿Cómo demonios se creó el mundo? ¿De dónde han salido todas estas cosas? ¿Por qué se sostiene en pie la Barbie con esos pies tan enanos?
Mi madre lo debió ver claro pues con tres años le pregunté que de dónde venían los objetos que nos rodeaban. Para salir del apuro me dio la respuesta sencilla: que todo lo que no habían hecho los hombres lo había hecho Dios. Rápidamente le contesté que esta era una pregunta seria, que no valía el típico cuento del hada madrina convirtiendo calabazas por doquier. Lo mismo mi pobre madre resulta tener razón, pero a mí eso de que me diera una explicación que no podía demostrar no me pareció nada serio.
La primera asignatura de física propiamente dicha que tuve se hizo esperar hasta los 16 años. Fue un flechazo. En las películas, a los adolescentes les meten en la cabeza eso de que cuándo conozcas al amor de tu vida lo sabrás de inmediato. Es mentira generalmente con las personas, pero no con la física. ¡Por fin un profesor se dedicaba a explicar cosas que eran verdaderamente útiles e interesantes! Alguien había desarrollado teorías y métodos matemáticos para explicar por qué funcionan las cosas, por qué y cómo caes más rápido según la inclinación de la cuesta, por qué en una olla a presión la comida se cocina más rápido, por qué los rayos de luz se curvaban en una lente, cómo se forma un arco iris, cómo se mueven las estrellas, cuánto tarda la luz del sol en llegar a tu terraza, por qué los aviones pueden volar, qué hace que funcione un microondas, de la inducción mejor ni hablamos (como veis la cocina me creaba grandes dudas), de qué está hecha toda la materia que nos rodea y, rizando el rizo, ¡cómo se creó!
Podría seguir un buen rato, pero el resumen es claro: POR FIN ALGUIEN SE MOLESTABA EN INTENTAR EXPLICAR CÓMO FUNCIONA EL MUNDO Y DE DÓNDE VIENEN TODAS LAS COSAS QUE NOS RODEAN. Incluso, lo de la Barbie.
La cuestión última de cómo se creó el universo fue la que dictó mis primeros años de carrera. El modelo del Big Bang había sido propuesto recientemente y devoraba artículos de divulgación sobre el desplazamiento al rojo, las curvas de rotación de las galaxias, los agujeros negros, etc. Estudiar asignaturas de astrofísica es una de las labores más satisfactorias que se me ocurrían pues ¿quién no quiere saber cuántos años tiene el universo? ¿Quién no se ha preguntado alguna vez si la Tierra ha existido siempre o cómo se han podido crear los planetas? ¿A qué distancia estará cada estrella en el cielo y si se estarán alejando o acercando? ¿Quién puede vivir sin hacerse esas preguntas? Nadie. ¡Nadie!
Bueno, entonces me eché un novio periodista que me hizo ver que no todo el mundo tiene esas inquietudes. Me confesó que cuando él miraba las estrellas lo que pensaba es "esa estrella me cae bien porque parece que me está guiñando un ojo, pero esa otra es una sosa, tremendamente aburrida…". Y a los cinco minutos sólo quería irse a tomar una cerveza. Reconozco que en ese momento pensé que no podíamos ser de la misma especie, que igual yo era muy rara. Bueno, no, pensé que él era muy raro, pero le tenía cariño. Y gracias a él entendí que la física convive con nosotros pero que, si te dejas llevar, puedes ser muy feliz aprovechándote de ella sin plantearte cómo funciona. Leche fría, minuto de microondas, magia, leche caliente. Pero si no hubiera gente como nosotros, gente que mete la báscula en el ascensor para ver cómo cambia tu peso aparente, mi novio periodista seguiría bebiendo la leche fría (cosa que a veces le deseo por lo mucho que se ha reído de mi experimento con la báscula).
Así que el resto de mi vida me empeñé en buscar explicaciones a tantas cosas que podrían considerarse magia. Creo que eso es a lo que se dedica un físico si consigue tener un poco de suerte: a intentar descubrir las leyes que gobiernan la naturaleza.
He tenido muchas veces una típica discusión con colegas científicos sobre si es más puro el conocimiento de las matemáticas que el de la física. Pero supongo que hay un gen materialista en mí y considero que, hasta que no se valida la teoría con la realidad pura y dura, el valor de la misma es muy limitado. Ello explica que haya acabado siendo física experimental y, aunque la física teórica me parece apasionante, nada garantiza que esa bella teoría de donuts en 11 dimensiones tenga más que ver con la realidad que lo de las mitocondrias de StarWars… ¡salvo que un experimento así lo demuestre! Y más allá, que emocionante es que un experimento te desvele un nuevo tipo de donut en el que nunca había pensado nadie antes.
Uno de los descubrimientos más importantes que uno hace cuando estudia Físicas es que el mundo es bello. Las teorías son bellas. La naturaleza tiende a hacer las cosas lo más sencillas posibles y todo es lo más bonito que uno pueda imaginar.
Lo bueno de la física es que cuando intentas responder a una de las preguntas más ambiciosas del mundo, la ya comentada cómo funcionan todas las cosas, las variantes son infinitas y cada día te encuentras resolviendo un determinado tipo de problema: cómo encajar los continentes como si fueran un puzzle, cómo construir un coche que levite, cómo construir un comedero de tortugas automático con esos relés que has conseguido por ahí, cómo sacar energía eléctrica de las olas, cuál es la edad del universo… En fin, la mayoría de la gente que te conoce piensa que estás mal de la cabeza, pero tu tortuga te está eternamente agradecida (al menos la mía lo estuvo).
Habrá momentos de duda, en las que necesites algo menos abstracto. Puede que empieces a dedicarte a algo más concreto y tu vida te lleve a fabricar radios con el último condensador que pillas por ahí. Y, claro, acabas pensando que una ingeniería de telecomunicaciones o electrónica te va a ir más. A mí me pasó. Hubo un par de años que hice una ingeniería de segundo grado en electrónica, coqueteos de la vida. Pero, claro, es que resulta tremendamente atractivo cómo se fabricaban los demultiplexores y se construye la lógica digital de nuestros ordenadores. Resulta que su funcionamiento tiene sentido y es muy entretenido, un sudoku muy friki.
Pero, al final, tuve que volver a la física. No lo pude evitar. Quedaban muchas respuestas en el universo a las que buscar explicación y, sobre todo, hay algunas, las que se engloban dentro de la investigación básica, que tienen un atractivo indescriptible. Casualmente, son cosas que no afectan mucho a tu día a día. No hacen que tardes menos en llegar al trabajo, no te quitan el calor en verano, ni te van a ayudar demasiado a ligar en los bares al sacar el tema… pero si te has quedado enganchado con preguntas como por qué la velocidad de rotación de las galaxias parece no cumplir las leyes de Newton (la típica duda), si será posible que esas estrellas lejanas estén hechas de antimateria o por qué la masa de la partícula top parece ser la suma de la masa del W y del Z (no entiendo cómo Netflix no ha hecho aún una serie de esto), es que la física de partículas está llamando a las puertas de tu mente y es difícil escapar. Avisado quedas.
Y eso también es lo bonito, se trata de intentar responder todas las preguntas del universo. Ahí, sin ambición.
Ser físico no es como ser bombero, que está claro que te vas a dedicar a apagar fuegos. Ser físico es, tratar de resolver una nueva pregunta hoy, fabricar un ordenador cuántico, medir la velocidad de los neutrinos, descubrir un nuevo planeta… Soñar cosas imposibles y hacerlas posibles.
Es un objetivo tan ambicioso, tan inabarcable, que en algún momento tienes que asumir que debes centrarte en algo (y ganar algo de dinero). Muchas veces es el propio camino el que te lleva a tu destino sin que te des cuenta. Hay tantas preguntas por resolver, que son las propias preguntas las que te acaban dando una respuesta. Mi respuesta acabó siendo participar en el descubrimiento del bosón de Higgs. No está mal, acabo dando un Nobel.
La vuestra puede ser, cualquier otra. Hay infinitas. Lo mismo descubrís cómo teletransportarnos (de una maldita vez), cómo crear filetes con la impresora 3D o cómo eliminar los residuos radioactivos.
Así que, ¿por qué ser físico? Primero, porque te gusta y bueno, también porque alguien tendrá que explicar cómo funciona todo esto y por qué sigue de pie la Barbie.
Cristina Fernández Bedoya
Doctora en Ciencias Físicas
CIEMAT (Centro de Investigaciones Energéticas Medioambientales y Tecnológicas)
"En marzo volvieron los gitanos. Esta vez llevaban un catalejo y una lupa del tamaño de un tambor, que exhibieron como el último descubrimiento de los judíos de Ámsterdam. Sentaron una gitana en un extremo de la aldea e instalaron el catalejo a la entrada de la carpa. Mediante el pago de cinco reales, la gente se asomaba al catalejo y veía a la gitana al alcance de su mano. "La ciencia ha eliminado las distancias", pregonaba Melquíades. "Dentro de poco, el hombre podrá ver lo que ocurre en cualquier lugar de la tierra, sin moverse de su casa"(1).
Y ese día llegó hace ya algunos años. No estoy en Macondo, ni en algún lugar inventado donde uno puede reconocer cierto pueblo de Colombia. Tampoco me acompaña un gitano viajero e ilustrado, Melquíades, que me muestra inventos exóticos y maravillosos traídos de lugares remotos. Estoy en un pequeño pueblo del Aljarafe sevillano llamado Umbrete. Son las 8:00 de la mañana del mes de diciembre del año 2017 y espero a que mis hijos se despierten para empezar la rutina de cada día. Para matar el rato, jugueteo con mi teléfono móvil. Entonces me conecto indiscreta con mi Android de última generación a earthcam.com (2). Veo rostros desconocidos. Uno de ellos, una chica rubia y alta, acaba de subir a un taxi amarillo justo en la esquina de las calles 47 y Broadway en Nueva York. Un chico corría tras ella agitando un sobre que llevaba en la mano pero no la ha alcanzado a tiempo. Son 5738 km de distancia desde mi casa a ese lugar del mundo en Norteamérica pero me puede secretamente la curiosidad ¿qué dirá esa carta?
Cien años de Soledad se desarrolla desde mediados del siglo XIX hasta mediados del siglo XX. Desde entonces, el mundo ha cambiado mucho. De manera vertiginosa. De eso me ha servido ser física electrónica, me ha servido para entender por qué y cómo se ha producido ese cambio y, quizás, para contribuir con mi pequeño granito de arena a los siguientes cambios que seguro llegarán a nuestras vidas en los próximos años. Cuando era pequeña (en los años 80) no había internet en las casas y nadie tenía un teléfono móvil en su bolsillo con el qué poder visualizar lo que ocurría a miles de kilómetros de su casa. Eran otros tiempos, muy diferentes a los de ahora. Ahora cada día manejamos muchos dispositivos electrónicos, pequeños, portátiles, fáciles de usar, que están al alcance de nuestra mano y, con ellos, podemos "hacer la magia" de comunicar cualquier contenido a cualquier otra persona del planeta, en cualquier momento, en cualquier lugar, de cualquier manera (podemos verlo, escucharlo, imprimirlo, modificarlo, reenviarlo,…) e incluso podemos cambiar configuraciones de objetos en nuestros hogares, lo que conocemos por domótica, o también dotar de internet a las cosas. Son muchas las aplicaciones informáticas que usamos sin parar. Hablamos con familiaridad de Facebook, WhatsApp, Twitter, Instagram y un sinfín de herramientas informáticas apps, ¡vaya palabreja!, que configuran nuestros modos y hábitos sociales; pero ¿tenemos una idea de lo que hay detrás de esos programas y qué les permiten cumplir su función? Si fuéramos capaces de usar algunos de los inventos de Melquíades para mirar dentro de los aparatos electrónicos que tenemos alrededor, veríamos que todas esas apps dependen para su funcionamiento de procesos de conducción eléctrica en sólidos; resumiendo mucho, del movimiento de una partícula elemental que ahora nos resulta familiar: el electrón. Un término que usamos en nuestro lenguaje cotidiano, aunque no sepamos muy bien qué significa. Pero el electrón no es una realidad visible para nosotros; solo lo son los equipos electrónicos y, en ellos, si los abrimos, sus componentes básicos: condensadores, resistores, bobinas, y unas cucarachitas con pinchos por patas que llamamos chips. Sin embargo, si uno estudia física electrónica, ingeniería electrónica, o telecomunicaciones, tendrá el conocimiento y la base para concebir cómo están relacionados esos dos conceptos clave, electrón y chip y, comprender, con razonable lujo de detalles, el camino que nos ha conducido hasta estos instrumentos (estos milagros) tecnológicos que tanto utilizamos y de los que tanto dependemos. Incluso uno podría ir más allá y contribuir activamente en la evolución de esta ciencia o tecnología, la Electrónica, de la que parece que nadie duda que seguirá marcando nuestro mundo futuro, al menos en el corto y medio plazo. Y es que la Electrónica ha evolucionado en poco más de cien años hasta trascender su papel como ciencia y tecnología y convertirse en un "fenómeno¨ o "vector" social y en una seña de identidad de nuestro momento histórico. Esto ha sido posible gracias a proporcionarnos una extraordinaria capacidad de comunicación y unas enormes posibilidades de cómputo, todo ello puesto al alcance de nuestra mano en forma de terminales muy accesibles y manejables. ¿Quién actualmente no tiene un teléfono móvil en el bolsillo o en el bolso? Si alguien no lo tuviera lo miraríamos como un auténtico bicho raro.

Como le pasa a la pobre Mafalda en esta viñeta de humor… (Original Crédito Quino)
Ya en1909, el gran Nikola Tesla aseveraba en un artículo visionario
"Pronto será posible que un hombre de negocios en Nueva York dicte instrucciones y que al instante aparezcan en su oficina en Londres o en otro lugar... Un instrumento barato, no más grande que un reloj, permitirá a su portador escuchar en cualquier lugar, en mar o tierra, la música o la canción, la voz de un líder político, la dirección de un eminente hombre de ciencia, o el sermón de un clérigo elocuente, generado en otro lugar, por muy distante que sea. De la misma manera, cualquier imagen, carácter, dibujo o impresión se podrá transferir de un lugar a otro".
Ese momento ya llegó hace un tiempo, lo estamos viviendo cada día, para bien o para mal, con el desarrollo tecnológico que está al alcance de nuestras manos. Sin embargo, poco es lo que el hombre de la calle conoce sobre qué es lo que hace posible esta tecnología, la Electrónica. Me atrevo a afirmar que todos vosotros, mis queridos lectores, conoceréis a Albert Einstein y nadie dudará que era una mente brillante cuyos estudios y descubrimientos han repercutido en mejorar nuestra vida actual y nuestra sociedad. Incluso muchos sabréis que ganó el Premio Nobel de Física en el año 1921 y que le fue otorgado por sus aportaciones a la Física Teórica, en especial por su descripción y formulación del efecto fotoeléctrico. Ahora bien, si menciono a William Bradford Schockley, John Bardeen y Walter Houser Brattain, probablemente estos nombres sean completamente desconocidos para la mayoría de vosotros. No obstante, estos tres hombres propiciaron esta revolución social de la que estoy hablando y en la que estamos inmersos. Cualquier experto en la materia se atrevería a afirmar que dichos hombres inventaron uno de los dispositivos más importantes de la historia de la humanidad, y, sin duda, el más representativo del siglo XX. Ellos fueron los padres del transistor y, por tanto, los responsables indirectos de la existencia de los aparatos y equipos electrónicos que usamos diariamente y de forma tan masiva. En 1956 estos tres físicos estadounidenses fueron galardonados con el Premio Nobel de Física por su investigación en semiconductores y el descubrimiento del efecto transistor. Pero ni alcanzaron una fama generalizada ni se hicieron ricos. Curiosamente, Bardeen, además, fue la primera y única persona en ser galardonada dos veces con el Premio Nobel de Física. Desgraciadamente, no goza de popularidad y nadie apenas lo conoce como a Einstein, por ejemplo. Él fue un físico teórico, un físico matemático, muy brillante pero muy modesto. Una vez leí que el periódico Chicago Tribune detalló adecuadamente el papel de Bardeen en la historia:
"Para los científicos Bardeen es un Einstein. Para el público en general es un… ¿John qué?"
Por todos estos motivos, por la curiosidad de conocer cómo funciona internamente cualquier dispositivo electrónico, por saber cómo ha sido la evolución tecnológica asociada a dicho dispositivo y quienes han sido los protagonistas de la historia científica que nos ha llevado a tener todo ese desarrollo electrónico al que tenemos acceso actualmente, por todo ello: YO QUIERO SER FÍSICA ELECTRÓNICA.
Y voy más allá, si analizamos la evolución de la Electrónica desde el invento del transistor, año 1947, hasta nuestros días y todo lo que ha significado para conformar nuestra realidad cotidiana, se puede describir así: «Si la automoción hubiera experimentado un desarrollo parecido al de la industria del transistor, se podría disponer de un Rolls-Royce por menos de 3000 pesetas (50 €) y, además, el vehículo dispondría de la potencia de un trasatlántico como el Queen Elizabeth para ser capaz de recorrer un millón de kilómetros (unas 25 vueltas al mundo) con sólo un litro de gasolina» (3).
Pero toda evolución tiene un límite y, actualmente, muchos se preguntan si hay "vida" después del transistor; si la Electrónica podrá seguir atendiendo a las necesidades y expectativas generadas. Muchos son los retos a los que nos enfrentamos los científicos dedicados a esta tecnología si queremos mantener este ritmo de crecimiento y progreso. YO QUIERO SER FÍSICA ELECTRÓNICA para inventar otro dispositivo distinto, un nuevo paradigma, una nueva solución, que resuelva los problemas que hoy en día presenta la Electrónica y todo su desarrollo tecnológico…
Notas:
(1) Cien años de Soledad, Gabriel García Márquez, 1967.
(2) Earthcam.com es un portal en Internet que transmite imágenes en vivo de distintos lugares del planeta.
(3) Fragmento sacado de la referencia "BARCELÓ, M. (1995). Prólogo de «El Mundo Digital» de Nicholas Negroponte, 7-14. Ediciones B, Barcelona"
Gloria Huertas Sánchez
Doctora en Física, Profesora Titular, Departamento de Electrónica y Electromagnetismo, Universidad de Sevilla.
La curiosidad
¿Qué es el físico? Si tuviésemos que responder a esta pregunta, sin duda diríamos que ante todo es un ser curioso.
Cuando somos niños, alrededor de los cuatro años de edad, sentimos un impulso que nos lleva a una explosión de porqués. "Mamá ¿por qué el cielo es azul?". "Papá, ¿por qué flotan los barcos?". Y así sucesivamente. Este elevado número de preguntas vuelve locos a nuestros padres y a todos cuantos nos rodean. Lamentablemente con los años esta curiosidad, esta sensación de maravilla y sorpresa ante el mundo, se extingue en algunas personas. Puede que, por la fuerza de la costumbre, lo que nos rodea deje de impresionarnos y nos refugiemos en la excusa del "siempre ha sido así". El hielo siempre ha flotado sobre el agua a pesar de ser sólido, el Sol siempre ha salido por el Este al amanecer, la lluvia siempre ha caído hacía abajo, mi café siempre se enfría si espero unos minutos… Pues bien, un físico no acepta el argumento del "siempre ha sido así". Los científicos cuestionan cada uno de estos fenómenos, y lo que es más importante, intentan darles una explicación razonada, sin recurrir a mitos o leyendas.
El método científico
El método científico, es una aproximación al estudio de la realidad, a la búsqueda de respuestas a esos porqués, a través de un enfoque empírico y deductivo, es decir, a través de la experimentación. Todo experimento que se precie debe ser repetible y refutable. Repetible en el sentido de que cualquier persona, en cualquier lugar, pueda reproducirlo obteniendo resultados idénticos. Refutable en el sentido de que admita la posibilidad de que diferentes diseños en los que se tengan en cuenta parámetros distintos puedan matizar los resultados previos o incluso desmentirlos. Los físicos huyen de las verdades absolutas, dejando la puerta abierta a nuevos descubrimientos o enfoques, siempre que éstos estén razonados y sean demostrables. Ésta es una de las grandes fortalezas de la ciencia, que se revisa continuamente a sí misma, que no es pretenciosa ni absolutista, que no se cree en posesión de la verdad, sino que se aproxima a ella, actualizándose, dudando continuamente.
Las unidades
Siempre que hablamos de experimentar hablamos de medir, y medir es comparar. Cuando una persona dice que tiene una masa de 75 kilogramos, está comparando su masa con la de 1 kilogramo y diciendo que es 75 veces la de éste. Por eso muy pronto los seres humanos se dieron cuenta de que era muy importante tener unidades, cantidades estandarizadas con las que comparar cada magnitud física o propiedad medible. Imaginemos que tienes un amigo en Groenlandia con el que sólo te comunicas por teléfono y queréis comparar vuestras alturas. Ninguno de los dos tiene una cinta métrica a mano, así que decidís usar las palmas de vuestras manos. Suluk te dice que su altura son 9 palmos y tú aseguras que la tuya son 10. ¿Significa eso que tú eres más alto? No tiene por qué. Ten en cuenta que nunca habéis comparado las palmas de vuestras manos y no sabéis si son iguales (requisito fundamental para usarlas como unidad de medida). Hagamos una pequeña cuenta, supongamos que la palma de tu mano mide 18 cm y la de Suluk 20 cm:
- Tu altura será: 10 palmos·18 cm/palmo = 180 cm = 1,8 m
- La de Suluk será: 9 palmos. 20 cm/palmo = 180 cm =1,8 m
¡Suluk y tú tenéis la misma estatura!
Los científicos necesitaban poseer una referencia universal y única con la que comparar sus mediciones, por eso se crearon los sistemas de unidades. Actualmente usamos el Sistema Internacional, que está compuesto de siete unidades de medida básicas que sirven para medir siete magnitudes fundamentales [1].
| Magnitud | Unidad | Símbolo |
| Longitud | Metro | m |
| Masa | Kilogramo | kg |
| Tiempo | Segundo | s |
| Cantidad de sustancia | Mol | mol |
| Corriente eléctrica | Amperio | A |
| Temperatura termodinámica | Kelvin | K |
| Intensidad luminosa | Candela | cd |
El resto de magnitudes se denominan derivadas y pueden expresarse en función de las siete anteriores. Esto hace imprescindible definir de forma rigurosa cada una de las unidades fundamentales. Veamos cuáles son las definiciones de algunas de ellas.
El metro
Volviendo al problema de estatura con nuestro amigo Suluk, lo ideal sería usar ambos el metro como unidad de medida para comparar nuestras alturas, pero no tenemos cintas métricas a mano, debemos fabricarlas. Para fabricar un metro podemos usar una cinta de tela pero… no podemos hacerlo sin una referencia. El metro original fue definido en 1792 por la Academia de las Ciencias de Francia como la diezmillonésima parte de la distancia que separa el Polo Norte de la línea del ecuador, a través de la superficie terrestre. Como no resulta cómodo tender una cuerda desde el Polo hasta el ecuador y partirla en diez millones de fragmentos cada vez que se quiera fabricar una cinta métrica, en 1889 la Comisión Internacional de Pesos y Medidas creó una barra patrón de platino e iridio con dos muescas en su superficie que estaban separadas exactamente un metro.

Esta medida debía tomarse como referencia en unas condiciones ambientales determinadas, (recordemos que los metales se dilatan cuando aumenta la temperatura). Tener que ir hasta la Oficina de Pesos y Medidas en Sèvres, a las afueras de París, cada vez que queramos fabricar un metro resulta poco práctico, además hay que tener en cuenta que la barra original envejece y se desvirtúa con el tiempo. Necesitamos algo que sea asequible, universal y que no varíe, para que cualquier científico en cualquier parte del mundo pueda reproducirlo. Por todo esto, desde 1983 el metro se define usando luz, que tiene una velocidad constante en el vacío como bien apuntó Albert Einstein y un reloj muy preciso. Un metro es la longitud del trayecto recorrido en el vacío por la luz durante un tiempo de 1/299792458 de segundo [1].
El kilogramo
Para la unidad fundamental de masa se conserva en la misma Oficina de Pesos y Medidas un patrón de forma cilíndrica, con altura y diámetro iguales (39 mm), formado por una aleación de platino e iridio cuya masa es de exactamente un kilogramo [1]. Existen varias reproducciones oficiales que se utilizan para calibrar todo tipo de básculas e instrumentos. Su cuidado exige que se almacene en unas condiciones ambientales estrictas y su limpieza y manipulación requieren un complicado protocolo para no desgastarlo o dañarlo. Actualmente es la única unidad fundamental que todavía se basa en un patrón y no en propiedades o características físicas fundamentales. Se está intentando cambiar esta definición para no depender de un objeto físico concreto pero aún no se ha llegado a un consenso.
El segundo
Desde el principio de los tiempos los seres humanos han usado los fenómenos astronómicos para medir el tiempo, buenos ejemplos de ello son el día y la noche o las estaciones.

Anteriormente el segundo era definido como una fracción de tiempo del año solar medio, se usaba la cantidad de tiempo que la Tierra tarda en dar una vuelta completa alrededor del Sol y se dividía en muchas partes iguales llamadas segundos. Lamentablemente los ciclos astronómicos resultan no ser absolutamente precisos, y sus periodos cambian, aunque sea mínimamente, con el transcurso de los años. Como ya hemos visto, se necesita una definición muy exacta e invariable. Actualmente el segundo es la duración de 9192631770 periodos de la radiación correspondiente a la transición entre los dos niveles hiperfinos del estado fundamental del átomo de cesio 133, en reposo y a una temperatura de 0 K [1]. Expliquemos esta obtusa definición, los átomos son los ladrillos que forman la materia y están compuestos a su vez de partículas más pequeñas, electrones, protones y neutrones. Los electrones se encuentran en niveles u orbitales, podríamos describirlos como "carriles" por los que se mueven dando vueltas alrededor de un núcleo en el que se encuentran los protones y neutrones. Dependiendo del carril u orbital por el que se muevan, los electrones tienen una energía determinada y a veces "saltan" de un carril a otro. Si el nuevo requiere menos energía que el anterior, el electrón libera la que le sobra en forma de radiación. Esta radiación es una onda de una frecuencia muy precisa, lo que significa que los intervalos de tiempo entre sus oscilaciones (o periodos) son fijos, y puede usarse como reloj.
El mol
El mol es la cantidad de sustancia de un sistema que contiene tantas entidades elementales como átomos hay en 0,012 kilogramos de carbono 12 [1]. El concepto de mol se asemeja al de docena. Yo puedo comprar una docena de huevos (12 huevos) o una docena de coches (12 coches). Una docena son 12 unidades. Un mol es una cantidad algo mayor de unidades, concretamente 6,02214129 · 1023 unidades, o lo que es lo mismo, más de seiscientos dos mil trillones de unidades. Teniendo en cuenta que la población mundial cuenta con más de 7000 millones de personas [2], necesitaríamos multiplicarla por unos 100 billones para llegar a tener un mol de personas. Puede deducirse que esta cantidad tan grande es poco práctica para la vida cotidiana, pero muy útil cuando contamos átomos, moléculas o células, entidades minúsculas. Por poner un ejemplo, debido a su pequeño tamaño se estima que un ser humano puede estar compuesto de decenas de miles de billones de células [3].
Conclusiones
Con esta pequeña introducción al mundo de las unidades he intentado transmitir la idea de lo increíblemente laborioso y delicado que es el trabajo de un físico experimental. Debemos ser rigurosos a la hora de medir la realidad, de acercarnos al mundo. Es el deber de todo científico encontrar las respuestas a los interrogantes más básicos de la naturaleza. Puede parecer que este trabajo deriva simplemente en la satisfacción de una curiosidad innata en el ser humano, sin embargo, a raíz de los descubrimientos de la ciencia básica surgen infinidad de aplicaciones prácticas. Por ejemplo Wilhelm Roentgen en 1895, desarrollando una investigación con tubos catódicos, descubrió los rayos X [4]. A partir de ese momento fue posible observar el interior del cuerpo humano sin necesidad de causar un solo rasguño al paciente. Rudolf Ladenburg, en 1928, observó experimentalmente la primera evidencia de emisión estimulada de radiación, lo cual se quedó en una curiosidad de laboratorio [5]. Años más tarde usando este fenómeno se construyó el primer láser. Hoy sus aplicaciones son muy numerosas, desde lectores de DVD, hasta cirugía ocular, pasando por la holografía. Además, no debemos olvidar que aparte de las aplicaciones prácticas, las recompensas son infinitas, pues el saber, el conocer, el descubrir, aporta una dicha al ser humano que no es comparable a ninguna otra sensación.
¿Algún curioso en la sala?
Referencias:
[1] Oficina Internacional de Pesas y Medidas, "El Sistema Internacional de Unidades (SI)". 8ª Edición 2006. Centro Español de Metrología.
[3] Bianconi, E., Piovesan, A., Facchin, F., Beraudi, A., Casadei, R., Frabetti, F., .... "An estimation of the number of cells in the human body". Annals of human biology, 40(6), 463-471. 2013.
[4] Kendall Haven. 100 greatest science discoveries of all time. Libraries Unlimited. 2007. ISBN: 9781591582656
[5] Mario Bertolotti. The History of the Laser. CRC Press. 2004. ISBN: 9780750309110
Ángela Mediavilla Trabada
Licenciada en Física e Ingeniera de Telecomunicaciones.
Profesora en la Universidad de Burgos y del Colegio Liceo Castilla en Burgos.
Cuando acabé la carrera de físicas, estaba buscando un tema para hacer una tesis. Pensaba que los grandes temas eran la astrofísica o la física de las altas energías que se investiga en el CERN.

Fig. 1. Diagrama de fases de los cupratos.
Fui a hablar con una antigua profesora de mi Universidad que más tarde se convertiría en mi directora de tesis. Me habló de unos compuestos misteriosos, los cupratos, que eran superconductores de alta temperatura y no se sabía por qué. También me contó que la teoría de los metales convencionales no podía explicar la fase metálica de estos compuestos. Me enseñó el diagrama de fases mostrado en la Fig. 1 donde la temperatura es el eje vertical y el dopaje, en el que se cambia un elemento químico por otro de distinta carga, el eje horizontal. Todos los colores del diagrama tenían una historia larga que contar llena de misterios. En aquel momento no entendía bien de lo me hablaba pero estaba fascinada con el enigma que encerraba ese material. Vería muchísimas veces más ese diagrama de fases a lo largo de mi vida y aprendí que la disciplina que estudia las fases de la materia se llama Física de la Materia Condensada. Pero vamos por partes.
¿Qué es la superconductividad?
La superconductividad es una fase de la materia. Se caracteriza por dos atractivas propiedades, resistencia nula y expulsión de campos magnéticos. Esto último da lugar a espectaculares fenómenos de levitación.

Fig. 2. Un imán levita sobre un cuprato superconductor.
La levitación de la Fig. 2 la hemos mostrado muchas veces a estudiantes de primaria, secundaria y universitarios que nos visitan en nuestro centro de investigación. Muchos materiales pueden tener una fase superconductora pero se necesitan unas temperaturas bajísimas para poder observarla. La temperatura por debajo de la cual el material se vuelve superconductor se llama temperatura crítica. Esta fase se descubrió a principios del siglo XX y se tardó más de 50 años en entenderla. Los héroes de esta historia son Bardeen, Cooper y Schrieffer que explicaron la superconductividad en 1956 con su teoría BCS. Los electrones son los que gobiernan el comportamiento eléctrico y magnético de un material. Los electrones interaccionan entre ellos y con las vibraciones de los iones del material y este hecho da lugar a la resistencia cuando se aplica un campo eléctrico. Por debajo de la temperatura crítica Cooper descubrió que dos electrones podrían unirse si sentían una fuerza atractiva gracias a un conocimiento profundo de física cuántica. Bardeen tenía indicios de que esa fuerza atractiva surgía de las vibraciones positivas de los iones. Con estos ingredientes, Schrieffer construyó el estado cuántico colectivo macroscópico que explicaba el estado superconductor. La teoría BCS fue un gran éxito que explicaba las propiedades y los experimentos sobre la superconductividad. Además, gracias a ella, se entendió la fase superconductora de las estrellas de neutrones y dio lugar al descubrimiento del mecanismo Anderson-Higgs clave para la propuesta del bosón de Higgs.
Los primeros superconductores tenían una temperatura crítica de unos pocos Kelvin pero los cupratos de los que hablábamos al principio pueden llegar a 140K. Sin embargo, no conocemos el mecanismo de la superconductividad de estos compuestos. Los cupratos pusieron a la luz otros compuestos de los que se desconoce su mecanismo. En 2008 se descubrieron otros superconductores con temperaturas críticas altas: los superconductores de hierro, en los que estoy investigando ahora.
El concepto de emergencia
La superconductividad es un ejemplo de "estado emergente". Este concepto es por el que siento más atracción en mi investigación y es uno de los más profundos de la Naturaleza: la simplicidad emerge de lo complejo.

Fig. 3. Bailes una bandada de estorninos. Fotografía de Alain Delorme.
En el ejemplo del estado superconductor, en vez de tener el caos de 1022 electrones interaccionando entre si y con los iones que se encuentren en el sólido, emerge un estado cuántico colectivo macroscópico. Aunque las palabras son algo abrumadoras lo que emerge del caos de tantas partículas interaccionando es un solo estado colectivo.
Fuera de la física existen ejemplos muy notorios de este concepto, el movimiento colectivo de una bandada de pájaros, la conciencia que surge de la interacción de millones de neuronas, la vida o nosotros mismos también nos podemos ver como un estado emergente.
En todos estos ejemplos tenemos elementos constituyentes (electrones, pájaros, neuronas, células) que interaccionan entre si. De esta interacción emerge un estado (superconductividad, movimiento colectivo, consciencia, nosotros) que no tiene por qué tener que ver con sus elementos constituyentes. En física de la materia condensada tenemos herramientas para entender la emergencia. Estas ideas fueron brillantemente expuestas en el influyente artículo de Philip Anderson "More is different" (1972). Anderson también dio nombre a esta disciplina: física de la materia condensada.
¿Qué es la física de la materia condensada?
Como podemos intuir del ejemplo de la superconductividad, la física de la materia condensada estudia sistemas compuestos por un número enorme de átomos que interactúan y dan lugar a las distintas fases de la materia tales como las conocidas fase líquida y sólida u otras más exóticas como la magnética y la superconductora. Es decir, es la física de la materia de la que estamos rodeados. Supone un gran reto en investigación porque es imposible resolver por ningún ordenador un enorme sistema de ecuaciones acopladas que utilizan las reglas de la física cuántica. Los fundadores de esta disciplina, entre los que destacan el mítico Lev Landau y Anderson, muestran una enorme intuición para desentrañar los secretos de la materia. A ellos les debemos conceptos universales en física tales como la ruptura de simetría, el concepto de cuasipartícula y el mecanismo de Anderson-Higgs. Otro gran físico de la materia condensada, John Bardeen, fue el único en la historia en ganar dos premios Nobel de física, uno por la invención del transistor (1956) base de toda la computación actual y otro, como hemos visto, por su explicación de la superconductividad (1972). En total ha habido 29 premios Nobel en materia condensada.
La física de la materia condensada está detrás de grandes revoluciones tecnológicas como la electrónica que ha cambiado totalmente nuestra vida. La podemos encontrar en el corazón de los materiales con los que se hacen los dispositivos que usamos a diario tales como el móvil o el ordenador. De la física de la materia condensada también surgirá la nueva tecnología del futuro que nos permitirá mejorar la tecnología presente tal como las baterías, las células fotovoltaicas y crear nueva tecnología que ya está despuntando tal como la spintrónica, los ordenadores cuánticos y la tecnología superconductora. En investigación esta tecnología está muy dirigida a afrontar los grandes retos que se le presentan a la humanidad como la crisis energética.
La materia condensada ofrece la posibilidad de estar en contacto cercano con el experimento y de hablar con los experimentales. Los experimentos de materia condensada pueden realizarse en laboratorios medianos, son muy variados y existen muchos laboratorios en el mundo para poder contrastar.
Pero lo que a mí más me atrajo de la física de la materia condensada es ese comportamiento sencillo que emerge de la complejidad de enorme cantidad de partículas interaccionando. Ya hemos visto un ejemplo, el estado superconductor, veamos ahora otro: el concepto de cuasipartícula.
Cuasipartículas
Los electrones de un material que mencionábamos antes son ejemplos de cuasipartículas. Estos electrones tan familiares que transportan la corriente eléctrica. La corriente eléctrica es el mayor desarrollo científico que ha cambiado nuestras vidas. Pero, ¿qué son realmente estos electrones que viajan por el material? ¿Son los mismos que los electrones individuales? A partir de ahora a los electrones que transportan la corriente eléctrica les llamaré cuasielectrones.
Tenemos la imagen, y es la imagen que he usado implícitamente para explicar la superconductividad, de los cuasielectrones como pequeños puntos que fluyen a través de un material. Pero hay un secreto muy bien guardado de esta imagen: NO es correcta.

Fig. 4. Vista artística de un electrón en un sólido, la más común de las cuasipartículas. https://gravityandlevity.wordpress.com/
Los cuasielectrones son ondas de densidad de probabilidad. Son casi idénticos a los electrones en el vacío pero surgen del movimiento colectivo de muchísimos electrones que interaccionan entre ellos y con los iones siguiendo las reglas de la física cuántica. De nuevo algo simple surge de una gran complejidad. Por eso les llamamos simplemente electrones. La única diferencia notable es que la masa de los cuasielectrones es diferente a la de los electrones como los ingenieros electrónicos saben muy bien. Podríamos visualizarlos como una onda que surge al perturbar un lago (Fig. 4). Este descubrimiento fue uno de los grandes triunfos de la física del siglo XX y se denomina la teoría del líquido de Fermi. Fue desarrollada por Lev Landau que acuñó el nombre de cuasipartícula. La fase metálica de los cupratos y de otros compuestos en investigación no se puede explicar con la teoría del líquido de Fermi y esto es un gran rompecabezas para la comunidad científica.
El movimiento colectivo de las vibraciones de los iones del material es otro ejemplo de cuasipartículas llamadas fonones. Los fonones nos permiten entender el sonido. En este caso los fonones (partículas emergentes) no tienen nada que ver con los iones (partículas constituyentes).
Existen muchas más cuasipartículas y cada una de ellas tiene su propia historia. En los últimos años se han encontrado cuasipartículas que tienen sus análogas en la física de altas energías. Ejemplos muy sonados en investigación son los fermiones de Dirac del grafeno o las partículas de Majorana de los superconductores topológicos. Estas últimas han sido propuestas para la realización de ordenadores cuánticos.
Reflexión
Todavía es un misterio para mí entender porque cuando acabé la carrera no era consciente de los numerosos atractivos de la física de la materia condensada. Quizás es una disciplina todavía joven. En la física de la materia condensada se encuentran cuestiones fundamentales y misterios sin resolver, la posibilidad de crear nuevos materiales, realizar un variadísimo espectro de experimentos, crear dispositivos útiles para nuestro día a día y soluciones que nos ayuden a los retos a los que se enfrenta la humanidad. Os animo a que forméis parte de esta gran aventura.
Referencias:
[1] Elena Bascones, Maria José Calderón y Belén Valenzuela, Web para la enseñanza de la Superconductividad, http://www.icmm.csic.es/superconductividad/
[2] "Materia Condensada", GEFES, https://gefes-rsef.org/
Belén Valenzuela Requena
Doctora en Ciencias Físicas
Científica Titular del Instituto de Ciencia de Materiales de Madrid, CSIC
Capítulo 77
Y yo quiero ser...Física. O bióloga…No, ¡física mejor! ¿O mejor bióloga?
(Por Susanna Manrubia)
Y yo quiero ser...Física. O bióloga…No, ¡física mejor! ¿O mejor bióloga?
(Por Susanna Manrubia)
Nunca me ha resultado fácil escoger entre dos cosas que aprender, porque la elección implica que me voy a perder una. Y, en mi experiencia, todo tema en el que se profundiza es de potencial interés, despierta la curiosidad y puede desembocar en interminables pero deliciosos ratos dedicados a su estudio. Aunque, claro, también existen las preferencias innatas: desde pequeña sabía que mi inclinación tendía a la parte científica (eso a pesar de que me fascinan las lenguas y me disgustó verme obligada a renunciar a la asignatura de griego clásico cuando tuve que escoger ciencias…).

Fig. 1. "Musei Wormiani Historia", frontispicio del Museum Wormianum que representa el cuarto de las curiosidades de Ole Worm. Fuente: Wikipedia.
Convertirse en profesional de cualquier cosa es como avanzar en el jardín de senderos que se bifurcan, puesto que las decisiones se multiplican y no hacen más que estrechar el camino –o eso pareciera—. Nunca habría querido tener que elegir entre una ciencia y otra: si hubiera nacido en el siglo XIX habría sido naturalista. Siempre me he sentido especialmente atraída por una existencia bucólica donde la observación y la reflexión constantes sobre la naturaleza son las que proporcionan deleite y conocimiento. ¿Quién no querría tener una colección de fósiles y minerales, un herbario extenso, mapas celestes, cráneos, egagrópilas y plumas de todas las especies, árboles petrificados, conchas de los mares del mundo? Eso me preguntaba yo de niña, cuando mi idea romántica de la ciencia era un gabinete de las maravillas alojado en una enorme biblioteca en madera con olor a libro viejo, noches estrelladas pasadas al raso y algún que otro viaje exótico que me permitiera aumentar mis colecciones.
Pero seamos realistas: de haber nacido en el siglo XIX no habría existido la más remota posibilidad de cumplir ese sueño. Los entretenimientos de la filosofía natural estaban vetados a las mujeres y a la inmensa mayoría de los hombres. Hace doscientos años no era habitual tener educación superior, muchas veces reservada a unos pocos pertenecientes a familias acomodadas o nobles. Entre estos afortunados se contaban hombres que han pasado a la historia como Charles Darwin, Alexander von Humboldt, Jean-Baptiste Lamarck o Francis Galton.
Mi vocación innata, sin embargo, tampoco parecía tener demasiada cabida en el siglo XX, cuando ya todas las ciencias y las ramas del saber estaban etiquetadas y tenían sus ámbitos de estudio definidos. Esta situación perdura, si bien vivimos un renovado interés en aspectos interdisciplinares que parece estar aumentando entrado el siglo XXI. No deja de resultar curioso, porque bien pensado parece que dividir el conocimiento en áreas es como poner puertas al campo. Volviendo a las decisiones que hube de ir tomando, yo esperé casi al último día antes de escoger carrera, y al final puse física en primer lugar. La biología ocupó el segundo lugar, justo detrás porque no podía colocarla al lado. Y después escogí Ingeniería de Telecomunicaciones, que era lo que iba a estudiar mi mejor amiga. Como cualquier otra persona, yo vivía y vivo en comunidad y en relación con otros. Las decisiones vitales son un compromiso entre la cabeza y el corazón, entre la parte racional y la emocional, diría que de manera inconsciente intentamos escoger lo que creemos que va a hacernos más felices.
Acabé los cinco cursos de Física (especialidad en Física Teórica) en otros tantos años. Mi expediente no fue brillante, pero durante ese lustro hice otras muchas cosas, como aprender idiomas, trabajar en el Museo de la Ciencia de Barcelona (ahora CosmoCaixa), empezar la carrera de Biología y leer muchísimo, especialmente ciencia ficción y libros de ensayo escritos por autores que han dejado una huella indeleble en mí, como Isaac Asimov, Stephen Jay Gould o Gerald Durrell. También aprendí mejor qué significa la física y fui interesándome por aspectos más fundamentales. Tanto la relatividad como la física cuántica son fascinantes, así como los formalismos matemáticos que permiten comprender de manera cuantitativa la organización y el funcionamiento de muchos sistemas físicos, entendidos en su sentido más clásico.
Acabé la carrera y tuve mucha suerte con las personas que me rodearon aquellos cuatro años que siguieron a la licenciatura. Mi director de tesis era (es) físico y biólogo, e hice la tesis en coincidencia espacial y temporal con un informático, un físico y un biólogo. Fueron años apasionantes, aprendí mucho de todos ellos y juntos exploramos lo que entonces empezaba a llamarse Sistemas Complejos. Simplificando, podría decirse que las ciencias de la complejidad usan la mirada y la forma de análisis de la física para abordar el estudio de problemas en otras disciplinas, entre las cuales la economía, la biología, las neurociencias o la sociología. Aprendí sobre dinámica caótica, objetos fractales, criticalidad auto-organizada, propiedades emergentes, efectos colectivos, organización no supervisada, teoría de la información, sincronización y muchos otros temas fascinantes que no se enseñaban en ninguna carrera. No fueron, por otra parte, años fáciles: hasta el último año de mi tesis no tuvimos financiación en el grupo de investigación, compartimos un único ordenador (un 386, probablemente menos potente que cualquier Smartphone actual) y, como mi expediente no era suficientemente bueno, no conseguí una beca para hacer la tesis. ¡Pero me doctoré con una tesis sobre auto-organización en ecología y macroevolución!
La forma de trabajar de aquellos años me ha marcado profundamente. También descubrí un aspecto no siempre destacado de la vida del investigador: los viajes. Parte de mi trabajo había versado sobre la formación de estructuras espaciales en selvas tropicales, para lo que usamos datos recopilados en una zona de acceso restringido de la isla de Barro Colorado, en el canal de Panamá. Por una serie de circunstancias, acabé visitando esa isla invitada por el Instituto Smithsonian. Nunca olvidaré un martes en el que estuve navegando por el Surumoni, un río de aguas negras afluente del Orinoco, acompañando a uno de los investigadores locales a recoger semillas de las trampas que había colocado estratégicamente. Hay experiencias que el dinero no puede comprar, y la ciencia me ha proporcionado un buen número de ellas.
Tras mi doctorado realicé una estancia postdoctoral de cuatro años en Alemania, y después volví a España para trabajar como investigadora en el Centro de Astrobiología, en Madrid, recientemente inaugurado entonces. Allí pasé trece años hasta que me trasladé al Centro Nacional de Biotecnología, donde estoy desde el año 2014. Mi actividad principal sigue siendo el estudio de sistemas biológicos usando la mirada del físico y técnicas de modelización, computacionales y matemáticas. Con el pasar de los años he descubierto que lo que más me interesa es la evolución y los mecanismos que la permiten, y que ese tema vertebra todas mis contribuciones profesionales. Empecé en la macroevolución, pasé por la ecología y la dinámica de poblaciones y desde hace más de una década me intereso por la evolución molecular. Me gustaría hacer el camino de vuelta, y regresar al estudio de los patrones de extinción y especiación a gran escala conociendo mejor las bases moleculares de la adaptación. Intento siempre que todos los aspectos teóricos y formales que trato estén fundamentados en observaciones empíricas.
No tengo un perfil convencional ni hago investigación fácilmente clasificable. Tampoco sé muy bien cómo se llega a hacer lo que yo hago, creo que en mi caso es el resultado de una trayectoria muy personal. Me lleva un rato explicar a qué me dedico, no puedo condensarlo en dos frases, y eso en ocasiones confunde a quien pregunta. Pero para mí tiene todo el sentido. He tenido suerte, pero también he asumido riesgos. Por naturaleza disfruto estando fuera de la zona de confort, en centros donde mi investigación es distinta o incluso rara, pero donde los retos intelectuales y el aprendizaje son continuos. Tras veinticinco años dedicada a la ciencia, ¿me atrevería a dar algún consejo? Pocos: el camino a seguir es una elección personal. Ser un profesional de la investigación ni es fácil ni te hace rico, pero yo no cambiaría esta vida por ninguna otra. He visto lugares que de otra forma habría tenido vetados, conocido a personas de países de todo el mundo con las que he descubierto mayor afinidad que con muchos vecinos y, sobretodo, puedo aprender todos los días. Muchas veces me han preguntado para qué sirve lo que yo hago, y tengo dos respuestas. Si bien la ciencia básica no siempre puede aplicarse inmediatamente, el avance del conocimiento es imprescindible para fundamentar cualquier novedad susceptible de ser aplicada en un futuro. Por otra parte, pienso que el conocimiento per se tiene un valor intrínseco, igual que el arte o la literatura. En nuestras múltiples dimensiones como humanos no podemos reducir nuestro bienestar a la mejora de la medicina o de la tecnología. También saber cómo se comporta la naturaleza y conocer el porqué de las cosas nos proporciona satisfacción, mejora nuestra calidad de vida y, en suma, nos hace más felices.
Susanna Manrubia
Doctora en Física
Centro Nacional de Biotecnología (CSIC), Madrid
Empezamos con una historia.
En la segunda mitad del siglo XIX, (nacido el 23 de abril de 1858), vivía en Kiel, un joven estudiante muy brillante, Max Karl Ernst Ludwig Planck, familiarmente Max. Tenía intereses muy variados: matemáticas, astronomía y mecánica, pero también filosofía y música, tocaba piano, violoncello y órgano y también componía canciones, música instrumental y llegó a componer una opereta, titulada Die Liebe im Walde.
Acabado el equivalente al bachillerato Max tuvo serias dudas, sobre hacia dónde dirigir sus pasos intelectuales. El profesor de física Philipp von Jolly, le desanimó de estudiar física porque, según le dijo, en física estaba todo prácticamente descubierto opinión bastante común entre los físicos de la época. Planck le respondió que a él no le interesaba descubrir nada nuevo sino saber cómo funcionaba la naturaleza y por tanto conocer los fundamentos de la física. Al final, aunque no abandonó del todo la música se matriculó en la Universidad de Múnich donde bajo la tutela de Jolly inició su aventura universitaria con trabajos en física experimental, como la difusión del hidrógeno a través del platino caliente. Luego se interesó más por la física teórica. En la Universidad Friedrich-Wilhelm, fue alumno de físicos como Helmholtz y Kirchhoff. A los 21 años se doctoró en Múnich con una tesis sobre el segundo principio de la termodinámica.
Su gran contribución, aunque no única, al avance de la física, fue la hipótesis cuántica, presentada en 1900 para explicar la radiación del cuerpo negro, según la cual éste emite energía en forma de "paquetes discretos", cuantos, según la fórmula simplificada  donde ν es la frecuencia de la radiación emitida y h es una constante que lleva su nombre. Esto suponía un cambio radical en la física y el nacimiento de la física cuántica desarrollada por talentos de la talla de Einstein, Heisenberg, Born, Bohr etc. En 1918 recibió el Premio Nobel de física precisamente por la creación de la mecánica cuántica. Falleció en Gotinga el 4 de octubre de 1947.
donde ν es la frecuencia de la radiación emitida y h es una constante que lleva su nombre. Esto suponía un cambio radical en la física y el nacimiento de la física cuántica desarrollada por talentos de la talla de Einstein, Heisenberg, Born, Bohr etc. En 1918 recibió el Premio Nobel de física precisamente por la creación de la mecánica cuántica. Falleció en Gotinga el 4 de octubre de 1947.
¿Qué es la "Física"? ¿Qué es un "Físico"?
Es una pregunta de difícil respuesta, aunque Planck la resumió muy bien: la física enseña a conocer los fundamentos de cómo funciona la naturaleza. También lo hacen otras ciencias, como la química o la biología, pero desde puntos de vista diferentes y posiblemente menos generales, y así la física abarca un espectro muy amplio: desde lo más grande, el universo, la cosmología, la astronomía y la astrofísica a lo más pequeño la estructura interna del átomo y la existencia y comportamiento de las partículas elementales. Importantísimo para la física es la materia, no solo en su constitución sino también en sus movimientos e intercambios energéticos. En resumen, todo bajo algún aspecto puede ser objeto de la física y como pretendía el joven Planck se trata de comprender los principios por los que el mundo funciona, es decir, esencialmente el físico debe descubrir conceptos observados en la naturaleza, a veces con sofisticados aparatos de observación y medida, otras con el poderoso instrumento mental que son las matemáticas y siempre con su ingenio. Esto se puede hacer desde dos puntos de vista complementarios, la física experimental y la teórica.
En la física experimental el físico busca observando directamente y reproduciendo en su laboratorio, si es posible, fenómenos de forma controlada buscando regularidades y las leyes que los rigen, que normalmente se expresan en forma de ecuaciones matemáticas. De esta forma se cumple uno de los objetivos, la posibilidad de hacer predicciones a plazo más o menos largo. Ahí surge un problema que el físico debe resolver. Las matemáticas son exactas, la naturaleza no lo es, además en la práctica nunca un suceso está aislado y todo experimento implica un error experimental.
El físico teórico opera utilizando sobre todo la herramienta matemática. Se puede decir que los teóricos trabajan de dos modos uno el que algunos llaman enfoque de arriba-abajo y consiste es establecer una formulación general y de ahí trabajar para encontrar una descripción del mundo o del problema que les ocupa en tanto que, en otro enfoque, de abajo arriba, el físico teórico parte de los hallazgos de la física experimental para ir creando gradualmente una teoría. La dificultad es que a veces no existen las matemáticas necesarias y hay que inventarlas, aunque nuevos descubrimientos matemáticos pueden inducir nuevas formas de estudiar la física, el descubrimiento en el siglo XVII del cálculo infinitesimal ayudó en gran manera al desarrollo de la física, proporcionando una herramienta de la que por ejemplo Galileo no disponía (tampoco disponía ni siquiera de un simple cronómetro).
Además de la física experimental y la teórica existe otro enfoque también muy importante que es la física aplicada que sirve la resolución de problemas en otras disciplinas, como la ingeniería, la medicina o lo biología.
¿Qué puede hacer un físico? ¿Dónde y cómo puede desarrollar su formación?
Hoy día las posibilidades del físico para ejercer su profesión son inmensas, posiblemente se una de las formaciones básicas más polivalentes.
El primer campo de trabajo es el académico ya sea como investigador ya como docente En la Universidad prima el físico especializado, el mundo de la física es tan grande que es imposible que una sola persona domine "toda la física".

Fig. 1. Laboratorio de Heinrich R. Hertz. Él mismo torneaba las esferas con las que realizaba sus experimentos.
Normalmente en los grandes centros de investigación se trabaja en equipo con integrantes de distinta preparación básica, con distintos intereses y diferentes habilidades.

Fig. 2. Vista aérea del CERN de Ginebra. Se superpone al paisaje el trazado de los túneles y la posición de los cuatro experimentos. Los túneles tienen del orden de 7 km de longitud.
Ha pasado a la historia el científico que trabajaba casi en solitario y con unos medios bastante elementales, como Hertz. Hoy la investigación profunda requiere grandes equipos materiales y humanos que solo grandes instituciones, públicas o privadas, pueden costear. A veces, como el CERN, se trata de proyectos internacionales.
El profesorado universitario normalmente compatibiliza su labor docente con su labor investigadora y su formación permanente es imprescindible por ejemplo mediante "años sabáticos" o estancias académicas en otros centros. Para el acceso a los cuerpos docentes e investigadores públicos se suele requerir una titulación que muchas veces implica el doctorado y superar unas pruebas: oposiciones.
Otra forma de ejercer la docencia es en centros de enseñanza secundaria o bachillerato en estos casos muchas veces la física se acompaña de química, aunque muchos titulados en física optan por las matemáticas, la informática o la tecnología. También se requiere una titulación y unas oposiciones, Fuera del mundo académico los profesionales de la física tienen un espectro muy amplio de actividad, aplicando directamente sus conocimientos en la industria, Los meteorólogos son en su mayoría físicos de formación y muchos físicos se especializan en otras ciencias de la tierra, como sismólogos, geofísicos, oceanógrafos, producción y transformación de energía. También son buscados en sectores como la banca, la defensa, incluso el comercio y por el método que da el estudio de la física en la resolución de muchos problemas y situaciones Especial interés tienen otros campos en que la física complementa otras disciplinas, como, la biofísica o la física médica, cuya importancia, y demanda de especialistas crece constantemente, En resumen, la polivalencia de los estudios de física es muy amplia.
¿Quiénes pueden estudiar física?
La carrera de físicas no es especialmente difícil, pero requiere además del interés y la curiosidad que son imprescindibles para quien quiera dedicarse a las ciencias, una buena base matemática y un cierto gusto por esta ciencia, al menos en sus aspectos operativos. También, para los aspirantes a físicos, gusto e interés por el trabajo de laboratorio con rigor y la precisión y no conformarse con los resultados trillados, ganas y capacidad para trabajar individualmente y en equipo. Son también imprescindibles los idiomas extranjeros, por lo menos una buena base de inglés, ya que este es la lengua franca de la ciencia, como en tiempos no muy lejanos fuera el latín.
¿Cómo son los estudios de física?
En España los estudios reglados empiezan por el Grado, que en teoría implica cuatro años de formación. Se tara de una formación bastante general en los campos que concierne a la física y que suelen cerrarse con un proyecto de investigación de fin de Grado. En muchos casos estos cuatro años no se consideran suficientes y es necesario complementarlos por "másteres" o maestrías, que suelen durar por lo menos un curso académico y que se trata de estudios muy especializados.
Finalmente está el máximo grado académico de la carrera que es el doctorado. Es un proceso de duración variable y que requiere el desarrollo y defensa ante un tribunal de un proyecto de investigación, la tesis doctoral. El doctorado es imprescindible para quienes se orientan hacia la Universidad o los centros especializados en investigación.
¿Dónde se puede estudiar física en España?
La mayoría de las universidades públicas españolas incluyen en su oferta el grado de Física. Bastantes de ellas ofrecen dobles grados es decir los planes estudio contienen un bloque de esas asignaturas comunes a ambos grados por separado y se incrementan con materias específicas, con la consiguiente ampliación de carga lectiva. El doble grado más común es el Física y Matemáticas, sin embargo, en algunas universidades se ofertan otros como Química y Física, Física e Ingeniería informática; Física y resistencia de materiales. También hay oferta de físicas en algunas universidades privadas.
En la Web se puede encontrar información actualizada (por ejemplo, en http://yaq.es/carreras-universitarias/ciencias/fisica) y en las páginas de las diferentes universidades se encuentra información más detallada.
Detalle importante es que para obtener una formación sólida es muy recomendable hacer alguna estancia en el extranjero por ejemplo acogiéndose a programas como Erasmus.
Resumen:
A quien le interese la ciencia y sienta curiosidad por saber cómo y por qué funciona el mundo el estudio de la física, le es imprescindible. Hoy una persona culta no debería ignorar los descubrimientos actuales de la física y este aspecto es muy importante por ejemplo para el profesional de la filosofía, incluso para el teólogo. No es necesario estudiar la carrera ni ejercer como profesional de la física, ni siquiera es imprescindible el dominio de las matemáticas superiores, se puede aprender física "sin matemáticas", basta con curiosidad y estar dispuesto a dedicar parte del tiempo a la lectura crítica de libros y revistas, en principio de divulgación, luego más serios. Hay excelentes libros divulgativos de diferentes niveles y escritos por los grandes maestros de la física, como Einstein, Heisenberg, Born, Feynman, etc. En realidad "Físico es todo aquel a quien le interesa saber cómo funciona el universo y trabaja para averiguarlo".
José Antonio Martínez Pons
Doctor en Química
Licenciado en Física
Sin duda todos nos planteamos en algún momento de nuestras vidas lo que queremos ser, lo que queremos hacer de nuestras vidas y qué papel queremos jugar en ella. Ya de niños nos peguntan con frecuencia: y tú ¿qué quieres ser de mayor? Y sorprendidos de tal pregunta, no sabemos muy bien qué responder, y a veces las respuestas son imágenes infantiles de nuestros héroes, tales como futbolista, bombero, enfermero o astronauta.

Fig. 1. La Termodinámica Cuántica es una de las novedosas disciplinas que está emergiendo en los últimos años y de las que se esperan grandes avances en el conocimiento básico y aplicado. Crédito: Prof. Jianshu Cao. MIT [3]
Comenzamos a adquirir conocimientos de física aproximadamente a los doce años, y con frecuencia ni siquiera somos capaces de clasificar los conceptos que adquirimos. Más tarde cuando tenemos cursos de física y química, o específicamente de física en el bachillerato, entonces comprendemos mejor de qué se trata. Además, hemos desarrollado paralelamente nuestros conocimientos de matemáticas, que nos permiten formalizar y modelizar los conceptos de la física de una manera más ordenada y rigurosa, sin perder de vista que se trata de una ciencia experimental.
Muy frecuentemente, al plantearse la cuestión de qué quiero ser, hay un primer paso: nos atraen las ciencias por encima de las humanidades y las ciencias sociales, o la ingeniería. Pero puede ocurrir que sigamos sin poder decidir cuál de las diferentes ciencias tradicionales, Física, Matemáticas, Química, Biología, Geología, es la que más nos atrae.

Fig. 2. Cuenca de atracción de un péndulo caótico. Cada color representa una región de condiciones iniciales que nos llevan a uno de los posibles movimientos del péndulo. Crédito: Dibujo realizado en el grupo de Caos de la Universidad de Maryland que dirige el Prof. James A Yorke.
Lo que nos hace decidirnos por una de ellas es algo muy personal, y las experiencias personales son muy variadas. Puede ser el haber tenido un excelente profesor que nos transmitió su pasión y entusiasmo por la materia, haber leído un libro apasionante de divulgación científica, haber visitado una feria de la ciencia, un planetario o un museo de ciencias, o muchas otras razones de índole interno que nos hacen sentir una atracción y un fuerte deseo de conocer más.
Es ese un momento clave, cuando en realidad, gustándonos las ciencias, además de las humanidades u otras materias, tenemos que tomar una decisión: la de comenzar los estudios del grado de Física en la Universidad. Cuando uno comienza sus estudios de Física en la Universidad, en la gran mayoría de los casos lo ignora casi todo de qué es realmente la Física y en qué consiste el trabajo de físico. Dicho de otro modo, qué puede hacer uno en la vida siendo físico. Esa visión genérica y tal vez inconcreta de la Física, se va aclarando poco a poco a medida que transcurren los diferentes cursos en qué consisten los estudios. Se nos van abriendo los ojos a nuevas e insospechadas disciplinas dentro de la física, que o bien ignorábamos por completo o tan solo teníamos una ligera idea al respecto. Descubrimos nuevos nombres, que designan disciplinas tradicionales o nuevas, tales como mecánica, termodinámica, física estadística, óptica, electromagnetismo, física de la materia condensada, física nuclear, gravitación y cosmología, física de la atmosfera, física no lineal y teoría del caos, física de sistemas complejos, física cuántica, biofísica, física de fluidos, acústica, física de partículas elementales, física matemática, astrofísica, física solar, geofísica, etc…El panorama que se nos ofrece es espectacular, las posibilidades innumerables, y eso que no las he mencionado todas.
Esta es una de las principales razones por las que he elegido como título de mi contribución "Y yo quiero ser...Físico" y no una especialidad en concreto, porque considero muy importante adquirir una formación básica y generalista, y a la vez estar muy abierto, de acuerdo a nuestras capacidades e inquietudes, a todas aquellas disciplinas que desconocemos y todas aquellas nuevas que surgirán a lo largo de nuestra vida profesional.
Sin lugar a duda, a lo largo de los años de nuestra formación, irán apareciendo disciplinas dentro de la física que nos atraen más. Pero insisto en que la primera decisión es "quiero ser físico". Es muy común que alguien idealice una determinada especialización por los motivos que sean, y que cuando se enfrente a la materia, se dé cuenta que no es lo que pensaba, o simplemente deje de interesarle. Pues no pasa nada. Lo importante es saber que con una formación básica podemos ser capaces de realizar funciones muy diferentes.
Es importante explorar la afirmación "Y yo quiero ser...Físico", pero también es importante saber qué es lo que hace un físico. Y un físico de hecho puede hacer muchas cosas. Una pasión de muchos es la de ampliar el conocimiento a través de la investigación científica. Otra posibilidad es la de aprovechar los conocimientos adquiridos en el grado de Física y emplearlos en una profesión donde se requiera la aplicación de conocimientos científicos y técnicos, y por último otra posibilidad tradicional es la dedicación a la enseñanza de la física. Todas ellas pueden ser apasionantes cuando realmente es lo que deseamos hacer.
Una de las vías más emocionantes, si tenemos la oportunidad de llevarla a cabo, es la ampliación de conocimiento a través de la investigación. Ello supone poder llegar a descubrir cosas nuevas que nadie haya visto anteriormente, y supone inventar cosas que puedan tener un impacto en la sociedad en la que vivimos y en el futuro de la civilización, estando en la frontera de la ciencia y del conocimiento. En general, y en función de la naturaleza de los problemas que atacamos o las preguntas que pretendemos resolver, la investigación puede ser básica o aplicada. Entendemos en general por investigación básica aquella que responde a un proceso impulsado por la curiosidad científica, lo que en algunos ambientes científicos recibe el nombre de curiosity-driven research.
Muchos de los grandes avances de la ciencia y de la física en particular resultan de afrontar con seriedad, método y rigor esta vía de conocimiento, la cual posteriormente a través de lo que se llama transferencia de conocimiento puede llegar a aportar numerosos resultados tecnológicos contribuyendo al desarrollo de nuestras sociedades.

Fig. 3. Dibujo del agujero negro llamado Cygnus X-1. Se formó cuando una gran estrella colapsó. Este agujero negro extrae la materia de la estrella azul a su lado. Créditos: NASA/CXC/M.Weiss [8]
Si bien existen muchos ejemplos, mencionaré tan solo un par de ellos. Hoy en día utilizamos sistemáticamente los GPS para orientarnos, y su propia existencia no sería posible sin el previo conocimiento de la llamada Teoría General de la Relatividad, que desarrolló hace más de un siglo el físico Albert Einstein. Todos los días usamos memorias USB u otros dispositivos de almacenamiento de memoria, así como discos duros de ordenadores, fruto de la aplicación de la llamada magnetoresistencia gigante que desarrolló tan solo hace unos pocos años el físico francés y Premio Nobel 2007 Albert Fert.

Fig. 4. Las ondas gravitacionales fueron detectadas en 2016. Los físicos estadounidenses Rainer Weiss, Barry C. Barish and Kip S. Thorne recibieron el Premio Nobel de Física en 2017 por su descubrimiento.
Dependiendo de la metodología usada, la investigación en física puede clasificarse en física experimental, física teórica, o física computacional, si bien las fronteras entre estas últimas son actualmente vagas, ya que los métodos computacionales son absolutamente necesarios hoy en día en casi todas las especialidades.
Para finalizar, quisiera enfatizar el hecho de que continuamente aparecen nuevos problemas de interés donde un físico puede desarrollar su trabajo de investigación y su creatividad, en numerosas ocasiones en problemas de naturaleza interdisciplinar, de ahí la importancia de formarse en aspectos básicos en varias disciplinas. Entre otros muchos ejemplos, puedo mencionar el auge que está teniendo la nueva y emergente disciplina denominada termodinámica cuántica [1,2,3], donde se pretende construir una nueva termodinámica para sistemas muy pequeños donde los efectos cuánticos no son despreciables. También en los últimos años ha habido un enorme desarrollo de lo que se conoce como dinámica no lineal, la teoría del caos y la física de sistemas complejos [4,5].
Otro campo emergente es la física del cáncer [6], donde métodos provenientes de la física y de la modelización matemática pretenden contribuir a comprender mejor qué es el cáncer y su dinámica.
El enorme interés que ha causado recientemente el descubrimiento de las ondas gravitacionales [7] a causa de la colisión de agujeros negros [8], presenta nuevos retos en los futuros avances fundamentales en astronomía y astrofísica. También son destacables los trabajos recientes del físico americano Douglas Stanford sobre caos y gravitación cuántica [9], donde usa aspectos de la teoría del caos para entender mejor la relación entre la física cuántica y los agujeros negros por los que ha recibido el prestigioso 2018 Breakthrough New Horizons Prize en física.
Todo ello sugiere que los problemas específicos de investigación en los que un físico va a realizar su trabajo son difíciles de predecir de antemano, ya sea porque las fuentes de financiación son variables con el tiempo, o bien porque continuamente están apareciendo nuevos retos apasionantes donde un físico puede desarrollar su creatividad y sus esfuerzos profesionales en aras de ampliar y difundir el conocimiento científico.
Referencias:
[1] Natalie Wolchover. The Quantum Thermodynamics Revolution. Quanta Magazine, May 2, 2017.
[2] Zeeya Merali. The new thermodynamics: how quantum physics is bending the rules. Nature 551, 20-22, November 2, 2017.
[4] Miguel A.F. Sanjuán. Introducción al caos determinista. Alambique: Didáctica de las Ciencias Experimentales 89, 41-48, 2017
[5] Las Matemáticas y la Física del Caos. Manuel de León and Miguel A. F. Sanjuán. Los Libros de la Catarata-CSIC, Madrid. ISBN: 978-84-8319-477-5 (2009).
[6] Vicente Crispín y Miguel A.F. Sanjuán. La Física del Cáncer. Revista Española de Física 30(1), 15-18, 2016
[7] Gravitational waves
[8] What is a Black Hole?
https://www.nasa.gov/audience/forstudents/k-4/stories/nasa-knows/what-is-a-black-hole-k4.html
[9] Douglas Stanford wins Breakthrough New Horizons Prize for work on chaos and quantum gravity
https://news.stanford.edu/2017/12/03/douglas-stanford-wins-breakthrough-new-horizons-prize/
Miguel Ángel Fernández Sanjuán
Catedrático de Física
Académico Correspondiente de la Real Academia Española de Ciencias
Director del Grupo de investigación en Dinámica No Lineal, Teoría del Caos y Sistemas Complejos Universidad Rey Juan Carlos Móstoles Madrid
¿De qué está hecho el Universo? Esa es la pregunta que mueve la Física de Partículas. A mí me enganchó cuando estaba en Secundaria, estudiando Química. Por aquel entonces, yo creía que los protones y neutrones del núcleo atómico y los electrones, colocados en esos orbitales con formas tan curiosas, eran los componentes básicos de toda la materia. Me encantaba mirar la Tabla Periódica, con todos los elementos tan ordenados, escribir ecuaciones estequiométricas asegurándote de que no se te perdía ningún átomo por el camino, dibujar estructuras de Lewis e imaginar cómo sería la molécula...
Pero entonces descubrí que todo eso se podía hacer con algo aún más fundamental: las partículas elementales. Resultaba que el protón no era una partícula elemental, sino que estaba compuesta por partículas más pequeñas, los quarks. En concreto, dos quarks up y un quark down. Los quarks up tienen una carga eléctrica positiva igual a 2/3 de la del electrón, los quarks down tienen un tercio de la carga eléctrica del electrón. Por eso la carga del protón es 2 × (+2/3) + 1 × (-1/3) = +1. En el caso del neutrón, está compuesto por un quark up y dos quarks down, por lo que la carga eléctrica total es cero. Los quarks además tienen una carga adicional llamada carga de color, y que puede ser roja, verde o azul (no son colores reales sino simbólicos, como el + y el – de la carga eléctrica). La interacción entre cargas de color se llama interacción fuerte, y es tan intensa que impide que los quarks puedan ser observados de manera aislada. Es esta fuerza la que confina a los quarks dentro del protón.
La tabla periódica de los físicos de partículas es la de la fig. 1. En ella se dividen las partículas que componen la materia en dos grandes grupos: las partículas que tienen carga de color se llaman quarks, las que no tienen, leptones. Todas ellas tienen espín, esa especie de momento angular intrínseco de la Física Cuántica, semi-entero, y por ello se les llama fermiones. En la primera columna, también conocida como primera familia, reconocemos los quarks up y down que acabo de mencionar, y el leptón más conocido, el electrón, que aprendemos en Química y que sí es una verdadera partícula fundamental. Además aparece el primer neutrino, el neutrino electrónico. Uno de los grandes misterios de la Física de Partículas es que hay dos familias más, y cada familia es esencialmente una copia de la anterior, pero con partículas más pesadas. No sabemos por qué hay tres familias y si podría haber más. Además, para cada una de las partículas que hay en la fig. 1 hay una antipartícula, una copia con la misma masa pero con carga opuesta.

Fig. 1. Los fermiones (partículas con espín s = ½) fundamentales. La masa (m) se da en unidades de energía (electrón-voltio, eV) dividida por la velocidad de la luz al cuadrado (c2); 1 eV/c2≈ 1.783 10-36 kg. La carga (Q) se da en unidades de la carga del protón. Los símbolos
Así, la materia está compuesta por partículas, y la antimateria está compuesta por antipartículas. Es curioso señalar que tres familias es el número mínimo para que la materia y la antimateria puedan comportarse de manera diferente, lo que podría estar relacionado con que vivamos en un Universo hecho de materia y no de antimateria.
Los físicos de partículas no investigan solo qué partículas existen sino cómo interaccionan entre sí también. La teoría física que describe las partículas elementales y sus interacciones se conoce como Modelo Estándar, y es el resultado de unir la Teoría Cuántica con la Teoría de la Relatividad Especial. Según este modelo, las interacciones entre partículas también están mediadas por otras partículas elementales con espín entero, conocidas como bosones (Fig. 2).
La interacción fuerte de la que ya hemos hablado está mediada por gluones, que portan una carga de color y una carga de anticolor (el equivalente del color para la antimateria). El hecho de que los propios gluones tengan carga de la interacción que median hace que, a pesar de no tener masa, su rango de acción sea extremadamente limitado, por debajo del diámetro de un protón. No obstante, es una interacción tan fuerte que incluso su componente residual es suficientemente intensa para vencer la repulsión eléctrica entre protones y permitir la formación de núcleos atómicos. La interacción electromagnética nos es más familiar, es la que mantiene a los electrones de un átomo ligados a su núcleo. Afecta a las partículas que tienen carga eléctrica. Su portador es el fotón, una partícula sin masa y sin carga que se propaga a la máxima velocidad posible en el Universo, la velocidad de la luz (c = 299792458 m/s). El alcance de la interacción electromagnética es infinito, pero a la escala de un protón es unas cien veces menos intensa que la interacción fuerte. La última interacción descrita por el Modelo Estándar es la interacción débil. Se llama así porque en la escala de un protón, es un millón de veces menos intensa que la interacción fuerte. La causa de esta debilidad es que sus mediadores, los bosones W± y Z0, son muy masivos (más de 80 veces la masa del protón), lo que a bajas energías hace que esta interacción esté suprimida. Esta interacción distingue misteriosamente entre izquierda y derecha, por lo que se dice que viola la simetría de paridad: sólo afecta a partículas que "giran" en la dirección contraria a las agujas del reloj (levógiras) o a antipartículas que "giran" en la dirección de las agujas del reloj (dextrógiras). Es más, esta interacción afecta de manera diferente a materia y antimateria.
Los físicos de partículas se suelen dividir en dos grupos: teóricos y experimentales; aunque la división no es infranqueable y hay físicos que combinan habilidades de distinta manera.

Fig. 2. Los bosones fundamentales del Modelo Estándar.
Los físicos teóricos trabajan desarrollando el Modelo Estándar; por ejemplo, calculando las probabilidades de que ciertos procesos se produzcan (la Física de Partículas es Cuántica, y sólo se puede hablar de probabilidades de sucesos) o intentando ampliar el Modelo Estándar con nuevas partículas para explicar misterios como qué es la materia oscura, esa sustancia desconocida que es necesaria para explicar observaciones astronómicas pero que no emite luz. Los físicos experimentales realizamos experimentos para comprobar la validez de esas teorías, medir parámetros fundamentales del Modelo Estándar o realizar búsquedas de nuevas partículas o interacciones. Los físicos de partículas experimentales encarnan una versión moderna del ideal renancentista de excelencia en "las armas y las letras", no sólo deben estar versados en las últimas teorías de Física de Partículas para poder ponerlas a prueba, sino que también deben ser capaces de diseñar, construir y operar los experimentos para ello, y analizar las ingentes cantidades de datos que producen.
En mi caso, yo estudio la física de neutrinos haciendo experimentos. De todas las partículas que componen el Modelo Estándar, los neutrinos son los peor conocidos. Sabemos que al menos hay tres tipos (o como decimos en Física de Partículas, sabores): electrónico, muónico y tauónico. No sabemos sus masas. Tenemos límites superiores resultantes de aplicar las leyes de conservación de energía y momento a desintegraciones que implican a neutrinos, y sabemos que no son cero porque hemos observado transiciones periódicas de sabor entre neutrinos, conocidas como oscilaciones, que solo son posibles si son partículas masivas. Esto es, neutrinos producidos con un sabor pueden ser detectados con otro sabor porque por el camino su sabor no está definido, sino que se encuentran en una superposición de los tres sabores, al igual que el gato de Schrödinger está a la vez vivo y muerto hasta que se abre la caja. La frecuencia con la que cambian de sabor depende de la diferencia entre las masas al cuadrado de los neutrinos, y por eso sabemos que no son cero.
Durante el doctorado trabajé en el experimento Double Chooz, que usa los antineutrinos electrónicos producidos en la desintegración radioactiva de los productos de fisión de la central nuclear de Chooz (Francia). Con un detector situado a 1 km de los reactores, contamos el número de antineutrinos electrónicos en función de su energía, descubriendo que había un déficit debido a que algunos antineutrinos cambiaban de sabor durante el trayecto. Actualmente, trabajo en los experimentos MicroBooNE y SBND en Fermilab en Estados Unidos. Nuestro objetivo es investigar una serie de anomalías que sugieren que podría haber más sabores de neutrinos que los tres conocidos. Para ello, usamos un haz de neutrinos predominantemente muónicos producido por la colisión de protones contra un blanco de berilio, que produce partículas inestables que acaban desintegrándose en neutrinos. Contando el número de neutrinos en función de su energía seremos capaces de determinar si se está produciendo una oscilación más rápida de lo esperado gracias al efecto de los nuevos sabores de neutrinos. Estos nuevos sabores tendrían una peculiaridad: no estarían sometidos a ninguna de las interacciones del Modelo Estándar, por lo que se los conoce como estériles. Y en el futuro, DUNE, un experimento en preparación, usará un haz de neutrinos que atravesará 1300 km de tierra para medir si los neutrinos oscilan con la misma probabilidad que los antineutrinos, en búsqueda de las claves de la prevalencia de la materia sobre la antimateria en el Universo.
Además, como los neutrinos únicamente experimentan la interacción débil, solo podemos afirmar con certeza que existen neutrinos levógiros y antineutrinos dextrógiros. Esto, unido al hecho de que tengan masas tan pequeñas, nos hace preguntarnos si los neutrinos obtienen su masa del campo de Higgs como el resto de las partículas masivas, o tal vez exista otro mecanismo. Una posible alternativa requiere que los neutrinos y los antineutrinos sean en realidad la misma partícula.
¿Cómo se llega a ser físico de partículas experimental? ¡Empezando en el colegio! Te tienen que gustar y se te tienen que dar bien la Física y las Matemáticas, y durante la carrera de Física profundizarás muchísimo más en ellas. Pero Lengua e Inglés son igual de importantes. No es posible hacer ciencia si no puedes comunicar tus conocimientos y discutir temas con tus colegas de manera efectiva. La Física de Partículas es una disciplina muy internacional, y el inglés es el idioma oficial. Cuando llegue el momento de elegir, busca una Universidad que tenga investigadores que trabajen en Física de Partículas y ve a hablar con ellos. ¡No seas tímido/a! Los primeros años de la carrera son comunes a todas las especialidades, y ahí aprenderás todas las herramientas matemáticas que usarás después y los fundamentos de Física necesarios para poder dar el salto a las asignaturas optativas: Mecánica Cuántica Avanzada, Teoría Cuántica de Campos, Física de Partículas... Aprender a programar es muy importante: la cantidad de datos que hay que analizar es enorme y se usan ordenadores todo el tiempo. Hoy en día, los lenguajes más usados en Física de Partículas son C++ y Python. Aprende también a usar el sistema operativo Linux y los comandos básicos de la shell. También te recomiendo que aprendas a usar uno de los editores Emacs o Vim, y software de control de versiones (por ejemplo, git). Si quieres saber más [1].
Referencias:
[1] J.I. Crespo-Anadón, I. Ochoa, C. Vilela et al., "Columbia University Science Honors Program Particle Physics", Web para la enseñanza de Física de Partículas, https://twiki.nevis.columbia.edu/twiki/bin/view/Main/ScienceHonorsProgram
José I. Crespo-Anadón
Doctor en Física
Postdoctoral Research Scientist, Nevis Laboratories, Columbia University
Supe de la existencia de una carrera universitaria en la que se estudiaba, sobre todo, física por un antiguo alumno del colegio donde yo estaba cursando el último año de bachillerato, que entonces se denominaba Curso de Orientación Universitaria, el famoso C.O.U. Acababa de terminar el primer trimestre y a una reunión de compañeros se sumó ese ex alumno que me dio la inesperada nueva: él estaba estudiando físicas en la Universidad de Granada. Por aquel entonces yo estaba convencido de que mi futuro iba a estar ineludiblemente ligado a la arquitectura. Pero parece que ese convencimiento no lo tenía suficientemente arraigado y a partir de aquel momento, y casi sin dificultad, torné mi interés hacia aquella entonces extraña Licenciatura en Ciencias Físicas de la que fui acumulando información y cuyos encantos acabaron embelesándome. Lo primero que aprendí al respecto fue que junto a la física se estudiaban muchas matemáticas, pero eso no constituía en mi caso ningún inconveniente: las matemáticas ya eran, junto con la física, objeto de mis preferencias como estudiante y, a diferencia de lo que me ocurría con otras asignaturas, me encontraba muy a gusto con ambas disciplinas. La perspectiva de pasar mi vida bregando con ellas no me resultaba nada desagradable.
¿Qué es la física nuclear?
Tuvieron que pasar cuatro años para que pudiera empezar a desentrañar los misterios de la física nuclear. Bueno, en realidad, supe algo de ella algún tiempo antes, cuando cursé el tercer año de la licenciatura y me topé de lleno con la mecánica cuántica, una disciplina que, aún no sé muy bien porqué, me hizo recuperar en todo su esplendor la ilusión con la que había empezado la carrera. Los números cuánticos, las funciones de onda, el principio de incertidumbre, los constituyentes de la materia, los potenciales, el momento angular, la teoría de colisiones… Todo aquello, que sonaba un poco a ciencia ficción (o directamente a chino según muchos de mis compañeros de clase), se me hizo enseguida familiar y me abrió la puerta a un campo de estudio en el que he seguido trabajando desde entonces y que tiene mucho que ver con la estructura de la materia.
Todos sabemos que la materia está formada por moléculas, unas estructuras más o menos complejas, constituidas por varios átomos. A su vez los átomos contienen un cierto número de electrones que orbitan alrededor de un centro de fuerzas, que tiene carga positiva y que, por medio de la fuerza de Coulomb, atrae a esos electrones. Como estos tienen carga negativa, se repelen mutuamente y son el balance de atracciones y repulsiones, junto con el propio movimiento de los electrones y del centro de fuerzas, los responsables de que los átomos existan como sistemas estables.
La física nuclear es la parte de la física que se concentra en el estudio de ese centro de fuerzas, el núcleo atómico. Aunque los núcleos tienen una estructura aparentemente simple, en realidad resulta muy compleja, con propiedades muy variadas. Para empezar cabe señalar que están constituidos por una amalgama de protones y neutrones que da cuenta de la mayor parte de la masa del átomo en el que se encuentra. Recordemos en este sentido que la masa del protón y la del neutrón (la de éste un poco superior a la de aquél) son, en números redondos, unas 2000 veces la del electrón. Atendiendo a la carga eléctrica, los sistemas atómicos pueden ser neutros, si el núcleo tiene un número de protones igual al de electrones, o, en caso contrario, estar cargados positiva o negativamente, denominándose entonces iones.
Pero como los neutrones son eléctricamente neutros, el número de ellos existente en el núcleo no cambia el estado de carga del átomo. Y no sólo eso: como las propiedades químicas de los átomos están relacionadas directamente con el número de electrones que contienen, el número de neutrones no las afecta. Surge entonces el concepto de isótopo: se llaman isótopos aquéllos átomos que se diferencian sólo en el número de neutrones contenidos en su núcleo, y el nombre proviene de que todos ellos se encuentran "situados" en la misma casilla de la tabla periódica. Los átomos conocidos son, por tanto, los que aparecen en dicha tabla, en la actualidad 118. Pero la existencia de isótopos hace que el número de especies nucleares sean mucho mayor y así, hoy día, son conocidas más de 3000 diferentes.
Estabilidad nuclear
La existencia de los núcleos atómicos fue puesta de manifiesto en 1911 por Rutherford y sus estudiantes Geiger y Marsden, después de realizar su famoso experimento en el que bombardearon con partículas  blancos de distintos materiales. Una de las primeras cuestiones que quedó clara entonces fue que las dimensiones características de los núcleos eran mucho más pequeñas (unos cinco órdenes de magnitud) que las de las órbitas de los electrones de sus correspondientes átomos; en otras palabras, que la materia que conocemos está, esencialmente, vacía. Pero no fue hasta 1932, coincidiendo con el descubrimiento del neutrón por Chadwick, cuando la estructura de los núcleos empezó a entenderse de manera correcta.
blancos de distintos materiales. Una de las primeras cuestiones que quedó clara entonces fue que las dimensiones características de los núcleos eran mucho más pequeñas (unos cinco órdenes de magnitud) que las de las órbitas de los electrones de sus correspondientes átomos; en otras palabras, que la materia que conocemos está, esencialmente, vacía. Pero no fue hasta 1932, coincidiendo con el descubrimiento del neutrón por Chadwick, cuando la estructura de los núcleos empezó a entenderse de manera correcta.
Casi inmediatamente surgió una cuestión muy relevante: ¿cómo es posible que un conjunto de neutrones y protones pueden formar un sistema estable a pesar de que éstos se repelen entre sí debido a su carga positiva? La respuesta resultó simple: existe otra interacción predominantemente atractiva y capaz de contrarrestar esa repulsión. Esa interacción es la denominada fuerza nuclear fuerte, que actúa sobre protones y neutrones y que tiene varias características que la hacen particularmente interesante. De ellas cabe destacar su intensidad, mucho mayor que la de la interacción electromagnética, y su corto alcance, que contrasta con el alcance infinito de ésta. Como consecuencia, la energía de enlace por nucleón (1) resulta ser prácticamente constante para todos los núcleos, del orden de unos 8 MeV/nucleón. Sin embargo, como puede verse en la fig. 1, hay pequeñas variaciones y son los núcleos alrededor del Fe los que presentan un mayor valor de esta cantidad, siendo, por tanto, los núcleos más estables.
¿Significa esto que hay núcleos inestables? La respuesta es sí y es importante señalar que de las 3000 especies nucleares conocidas, a las que antes he aludido, tan sólo poco más de 250 son estables, es decir, que no se ha podido observar, con la instrumentación existente hoy día, que sufran proceso de desintegración alguno. Por el contrario, los núcleos inestables se desintegran; en otras palabras, se transforman en otros núcleos emitiendo radiación o fragmentándose. Los procesos más usuales son los siguientes:
- desintegración α, en la que el núcleo emite una partícula α, que no es sino un núcleo de 4He;
- desintegración β-, en la que un neutrón del núcleo se convierte en un protón y se emite un electrón (y también un antineutrino);
- desintegración β+, en la que ocurre lo contrario, esto es, un protón se convierte en un neutrón y de resultas se emite un positrón (la antipartícula del electrón) y un neutrino;
- captura electrónica, proceso en el que el núcleo captura uno de los electrones del átomo en el que se encuentra, un neutrón se convierte en un protón y se emite un neutrino;
- desintegración γ, en la que un núcleo que queda en un estado excitado después de algún otro proceso, pasa a ocupar otro estado de menor energía emitiendo fotones, y
- fisión nuclear, que conlleva la fragmentación del núcleo en dos núcleos más ligeros y la emisión de varias partículas (como neutrones y fotones). La fisión es la base de la generación de energía en las centrales nucleares y los núcleos susceptibles de sufrirla son los más pesados, los que cuentan con muchos nucleones (ver fig. 1).
El escenario es pues más que interesante. Disponemos de un conjunto de varios miles de núcleos, de muy variada composición y que pueden bien ser estables o bien evolucionar de distintas formas.

Fig. 1: Energía de enlace por nucleón en función del número de nucleones, A, para distintos núcleos. La notación empleada para los núcleos indicados es AZ donde Z, el número de protones, se ha sustituido por el símbolo químico del átomo neutro correspondiente. Los núcleos pesados son menos estables que los de la zona del Fe, ya que tienen una energía de enlace por nucleón más baja, y podrían fisionarse, produciendo energía y transformándose en otros núcleos más ligeros, más estables. Por otra parte, dos núcleos ligeros podrían fusionarse, una vez vencida la repulsión coulombiana, dando lugar a otro núcleo más estable y produciendo también energía: estaríamos entonces ante la fusión nuclear.
Y no sólo eso sino que, además, las propiedades de estos núcleos pueden ser muy diferentes aún cuando no lo sea el número de los nucleones que los forman. Por ejemplo, el núcleo de 238Pu tiene un período de semidesintegración de 87.7 años, mientras que el del 239Pu es de 24110 años y sólo se diferencian en un neutrón. Otro ejemplo: el 1H es el isótopo del hidrógeno más abundante en la naturaleza (99.98%) mientras que el 2H, que tiene un neutrón más, sólo está presente en un 0.02%. Ambos son estables. Sin embargo el 3H, formado por un protón y dos neutrones, es radiactivo β-, tiene un período de semidesintegración de 12.32 años y algunas trazas de él pueden encontrarse en la naturaleza cuando se producen, por ejemplo, ciertas reacciones de interacción de rayos cósmicos con la alta atmósfera. Por lo demás se trata de un núcleo artificial que aparece, por ejemplo, en los reactores nucleares debido a las reacciones que ocurren en ellos.
Explicar las propiedades de todos estos sistemas requiere modelos de muy distinta índole que destaquen aquellas características más relevantes en cada caso concreto. La casuística es tal que aún quedan problemas por empezar a explorar. Y no sólo en el propio ámbito de la física nuclear, sino en otros tan aparentemente alejados del mismo como el de la astrofísica. Por citar uno de mucho interés en la actualidad me gustaría mencionar aquí el estudio de la abundancia de los elementos en el universo. La determinación de esa abundancia está ligada a la evolución de las estrellas y ésta, a su vez, al desarrollo de las distintas cadenas de desintegración nuclear en las que la aparición o desaparición de unos u otros núcleos ocurre con una determinada probabilidad que está regida por las propiedades de esos núcleos. No parece pues la física nuclear un mal campo de trabajo, ¿no?
Radiactividad y aplicaciones
La radiación emitida en los procesos de desintegración antes descritos entra dentro de la clasificación de radiación ionizante, ya que tienen energía suficiente para ionizar las moléculas y los átomos de los materiales con los que interactúan. Estamos hablando de la radiactividad, cuyas aplicaciones son numerosas en la industria y la medicina. Y esto incrementa notablemente las temáticas en las que los conceptos básicos de la física nuclear tienen una salida natural.
De especial interés en mi caso es la física médica, una disciplina a caballo entre física y medicina, en la que se estudian estrategias y aplicaciones de la física para la solución de problemas de índole médica. En ella tiene un papel estelar la radiactividad que ha permitido avanzar, de manera impensable hace tan solo unas décadas, tanto en el diagnóstico como en la terapia. En relación al primero basta mencionar todo lo relativo a la imagen médica (radiografía, mamografía, SPECT, PET, etc.), que tuvo su origen en el descubrimiento de los rayos X por Roentgen a finales del s. XIX. En cuanto a la terapia, no descubro nada nuevo aquí si aludo a las enormes mejoras alcanzadas en el tratamiento del cáncer con fuentes de radiación de muy distinta índole (isótopos radiactivos y aceleradores de electrones, de fotones, de protones y de iones pesados).
Conclusión
La física nuclear es una rama de la física que goza a día de hoy de una vitalidad reseñable. Tanto en lo que respecta a los problemas intrínsecamente propios, esto es lo que se refieren a los núcleos y sus propiedades, como los que han derivado de su capacidad para generar nueva ciencia en otras temáticas, como el caso de la física médica, hacen de ella una disciplina que contempla un sinfín de enfoques diferentes para la solución de las cuestiones abiertas. Se trata pues de una ciencia apasionante en la que aún queda mucho por hacer y las opciones de trabajo son reales. Las puertas están abiertas de par en par para los entusiastas.
Notas:
(1)Nucleón significa partícula constituyente del núcleo y hace referencia indistintamente a un protón o a un neutrón.
Antonio M. Lallena Rojo
Doctor en Ciencias Físicas
Catedrático de Física Atómica, Molecular y Nuclear.
Universidad de Granada
Cuando se piensa en los laboratorios necesarios para realizar experimentos con núcleos y partículas, inmediatamente nos vienen a la mente las grandes instalaciones que aparecen de vez en cuando en los medios de comunicación, como el Gran Colisionador de Hadrones (LHC, por sus siglas en inglés), que es el mayor de los aceleradores del CERN, en Ginebra. ¿Por qué se necesita un anillo de 27 km de longitud para estudiar partículas tan pequeñas que en muchos casos son consideradas como puntos matemáticos? La razón es que la teoría cuántica predice que cuanto más pequeña es la región del espacio que queremos explorar y más cortos los tiempos en que suceden los procesos, más amplios deben ser los rangos empleados de energía. Esta es una de las consecuencias más extrañas del mundo cuántico, que impone severas restricciones en el avance experimental de la disciplina.
Sin embargo, un físico nuclear y de partículas teórico se aísla en cierto modo de esas dificultades (y éxitos) de la ingeniería y concentra su trabajo en el verdadero laboratorio que ofrece la naturaleza para estudiar las partículas: el núcleo atómico. La utilidad de este microscópico sistema (del tamaño de una milbillonésima de metro, 10-15 m) es que las partículas interactúan en él y con él de muy diversas maneras, y del estudio de esos procesos se puede extraer una gran cantidad de información sobre la naturaleza de esas partículas o sobre la propia estructura de los núcleos y de los átomos. Buena parte de las interacciones entre partículas y núcleos no son más que choques entre ellos, que se denominan dispersiones o procesos de scattering. Se trata de la versión científicamente rigurosa de matar moscas a cañonazos, solo que en este caso no es sinónimo de método ineficaz sino de todo lo contrario, porque estudiando la energía con la que salen despedidas las partículas que chocan con los núcleos se aprende muchísimo de la física a escalas microscópicas. También son muy interesantes los procesos en que los núcleos emiten partículas espontáneamente, que se denominan desintegraciones radiactivas. Las más conocidas son la desintegración alfa (que emite núcleos del elemento helio), la beta (que emite electrones, neutrinos y otras partículas similares) y la gama (que emite fotones, como los de la luz visible pero mucho más energéticos).
Para entender mejor por qué los núcleos son tan buenos laboratorios para estudiar las partículas, es necesario retroceder a la física más fundamental que conocemos. En el nivel más básico de la naturaleza existen solamente, que sepamos, cuatro fuerzas distintas que actúan entre las partículas de materia. Reciben el nombre de interacciones fundamentales, y en la vida cotidiana estamos familiarizados con dos de ellas: la interacción gravitatoria y la electromagnética. La primera nos mantiene pegados a la superficie terrestre, además de retener a la Luna en órbita alrededor de la Tierra y a esta en torno al Sol. La interacción electromagnética, por su parte, es la responsable de todos los fenómenos eléctricos, magnéticos, ópticos y químicos que nos rodean. Las dos interacciones fundamentales restantes, por el contrario, no tienen efectos aparentes en las escalas de tamaño en las que vivimos, sino solo en la pequeñísima escala de los núcleos atómicos. Se denominan interacción fuerte e interacción débil, haciendo referencia a su intensidad. La primera es responsable de mantener unidas las partículas que forman los núcleos atómicos, protones y neutrones, y la segunda es la causante de una de las desintegraciones de las que hablábamos antes, la beta, entre otros procesos. El núcleo atómico es el único sistema físico complejo en el que intervienen tres de las cuatro interacciones fundamentales: la electromagnética (porque los protones tienen carga eléctrica), la fuerte y la débil. Por eso las partículas subatómicas que interactúan con los núcleos lo hacen de maneras tan variadas y revelando tanta información sobre su naturaleza.
La cuarta interacción, la gravitatoria, es mucho menos intensa que las demás, y no tiene apenas relevancia en procesos nucleares y de partículas. Pero sí interviene de manera esencial en otros objetos mucho más grandes de nuestro universo: las estrellas. Ellas constituyen el otro gran laboratorio de los físicos nucleares teóricos, ya que su estructura y comportamiento depende de las tres interacciones relevantes en la escala nuclear y, además, de la interacción gravitatoria. Efectivamente, el interior de las estrellas se rige por las leyes de la física nuclear, en concreto de la rama denominada astrofísica nuclear.

Fig. 1. Esquema de la estructura de la materia desde las escalas cuánticas hasta las astrofísicas, indicando los tamaños característicos y las interacciones fundamentales predominantes. La física nuclear y de partículas juega un papel esencial en el interior de los átomos y en el interior de las estrellas.
La ingente cantidad de energía que se libera en las estrellas procede de reacciones de fusión (unión) entre núcleos, que son también las encargadas de producir los elementos pesados en nuestro universo. A excepción del hidrógeno, el resto de elementos que forman parte de nuestro planeta y de nosotros mismos han sido creados en el interior de una estrella: somos, en sentido literal, polvo de estrellas.
Una de las características más seductoras de la física nuclear y de partículas es su carácter reduccionista, en el sentido de que describe los enormemente complejos procesos que ocurren en la naturaleza con sólo cuatro interacciones distintas actuando entre un conjunto reducido de partículas elementales. Para todo científico movido por una irreprimible necesidad de comprender el mundo en el que vive, esta simplificación aparece casi como una revelación. Sin embargo, el reduccionismo no es algo que deba llevarse demasiado lejos. ¿Se atrevería alguien a explicar el funcionamiento del cerebro humano a partir de las leyes de la mecánica cuántica que rigen el comportamiento de los núcleos y las partículas? Casi mejor no intentarlo. Para eso tiene la ciencia otras disciplinas más adecuadas a cada nivel de complejidad, como la química, la bioquímica, la biología, la psicología, etc. Pero no deja de ser cierto que, al menos en teoría, todas las leyes y principios del resto de ciencias naturales se podrían reducir a los de la física nuclear y de partículas, porque es esta la que contiene los ladrillos básicos de la materia, sus influencias mutuas y, en definitiva, las leyes más fundamentales del universo.
Además de su evidente relación con la ciencia básica, la física nuclear y de partículas tiene numerosas aplicaciones tecnológicas. Se emplea en el análisis de materiales, que son bombardeados por diversos tipos de partículas para estudiar su estructura; para estudiar procesos biológicos, geológicos o agrícolas mediante trazadores, que son moléculas que contienen átomos radiactivos; en diversos procesos industriales para medir el espesor de materiales, el nivel de llenado de recipientes, etc.; para esterilizar alimentos y materiales de uso médico; para la datación de rocas, restos biológicos, etc., como la conocida prueba del carbono-14; y otros muchos usos. Mención especial merece la obtención de energía de origen nuclear en forma controlada para impulsar vehículos (submarinos, sondas espaciales) o para ser transformada en energía eléctrica en las centrales nucleoeléctricas. En estas se aprovecha la energía liberada en reacciones controladas de fisión (escisión, ruptura) nuclear en cadena, que se pusieron a prueba por primera vez hace ahora 75 años en la denominada pila de Fermi, en honor al impulsor del proyecto, Enrico Fermi. De hecho, casi todas las fuentes de energía que aprovecha la humanidad en su beneficio proceden directa o indirectamente de la energía nuclear. Así, la energía solar térmica y fotovoltaica proviene indirectamente de las reacciones de fusión nuclear en el interior del Sol. Lo mismo ocurre con la energía eólica, de las olas y de las corrientes marinas, que se generan por la distinta incidencia de la radiación solar en diferentes regiones de la atmósfera o de los océanos. Las masas de agua situadas a cierta altura, cuya caída se aprovecha para la generación de energía hidroeléctrica, han llegado hasta ahí tras absorber radiación solar, evaporarse y finalmente caer en forma de precipitación. Por último, los combustibles fósiles y biocombustibles no son otra cosa que luz solar captada y almacenada mediante las reacciones fotosintéticas de las plantas.
Con mayor énfasis aún cabe reflejar aquí los usos médicos de las radiaciones nucleares, que tuvieron una de sus primeras aplicaciones en los coches dotados con máquinas de rayos X que ideó Marie Curie para atender a los soldados en la Primera Guerra Mundial. Los usos médicos incluyen métodos de diagnóstico, como las radiografías realizadas con los mencionados rayos X, y métodos de terapia, como las radiaciones ionizantes empleadas para el tratamiento de tumores. La fuente de las radiaciones puede estar encapsulada y situarse a cierta distancia del paciente, constituyendo los métodos radiológicos; o bien puede tratarse de fuentes abiertas y de radiofármacos que se inyectan directamente en el paciente, técnicas que se engloban en la medicina nuclear. Tampoco podemos olvidar el protagonismo que, por desgracia, ha tenido la física nuclear en los acontecimientos históricos desde mediados del siglo XX hasta hoy, a través de las armas nucleares, que emplean reacciones de fisión y fusión. La ciencia y la tecnología nucleares resultan imprescindibles para entender el devenir histórico de la Segunda Guerra Mundial, de la posterior Guerra Fría, y buena parte del statu quo geopolítico actual.
En definitiva, la física nuclear y de partículas nos permite comprender el origen y evolución de la materia tras el Big Bang, así como la creación de elementos pesados y la generación de energía en las estrellas, que es el motor del desarrollo de la vida y de nuestra civilización. Nos abre las puertas a la comprensión de los ladrillos básicos de la materia, para profundizar en los que ya conocemos y descubrir otros nuevos, como la materia oscura. Esto a su vez nos ilumina el camino hacia la comprensión del universo a gran escala, a través de los efectos gravitatorios y cosmológicos. Empleamos las radiaciones nucleares en multitud de aplicaciones industriales y tecnológicas, incluyendo la obtención directa de energía de la fisión nuclear, y quizá en un futuro también de la fusión nuclear, y para el diagnóstico y el tratamiento de enfermedades. Además, la física nuclear nos ofrece claves para interpretar los últimos 80 años de nuestra historia, con la vista puesta en no repetir los errores del pasado y en centrar nuestros esfuerzos en el avance tecnológico pacífico de la humanidad. ¿Quién da más?
Óscar Moreno
Doctor en Ciencias Físicas
Departamento de Estructura de la Materia, Facultad de Ciencias Físicas, Universidad Complutense de Madrid, y Grupo de Química y Física Teóricas, Instituto de Estructura de la Materia, CSIC
—Entonces, ¿quieres saber por qué sucedió?
—Sí, claro —respondo.
—La "Gran Tormenta Solar" —dice Montse tristemente—. Nos pilló con los pantalones bajados. Hasta los tobillos. A pesar de que sabíamos que podía pasar.
Estamos casi a oscuras, tan solo iluminados por algunas velas. Casi nada funciona: únicamente el reloj de pulsera de Montse y la radio (de pilas, claro). Desde la GTS, hace 3 meses, no hay electricidad. Y, por tanto, no podemos emplear los móviles, ni los electrodomésticos,... ni nada. En la calle no circulan vehículos a motor. Según Montse, esta situación va a durar muchos meses hasta que los transformadores de las centrales eléctricas sean reparados y se pueda "poner la civilización en marcha nuevamente".
—¡Vamos allá! —arranca Montse—. El Sol es una bola de gas de 700.000 km...
—¡Vaya rollo! —la interrumpo—. ¿No puedes ir al grano?
—Ja, ja. De acuerdo. ¿Tienes idea de por qué brilla el Sol? ¿No? Para empezar, en su centro la temperatura ronda los 16 millones de K. ¿Sabes que cuánto más alta es la temperatura, mayor es la velocidad de las partículas de un gas? Pues en el centro del Sol los protones se mueven a una velocidad media de más de 500 km/s.
—¿Y? —pregunto.
—Pues que a estas velocidades dos protones pueden vencer la repulsión de sus cargas eléctricas positivas y fusionarse para crear un núcleo de deuterio—Montse duda y se rasca la cabeza—. Bueno, un poco de Mecánica Cuántica vendría bien ahora...
—Me parece estupendo —ironizo—, pero ¿qué es el deuterio?
—¡Ah, sí! Mira, es un núcleo con un protón y un neutrón. O sea, es un isótopo de hidrógeno. Esto... ¿dónde estábamos?
Montse se para a pensar un momento.
—¿Por qué brilla el Sol?—le recuerdo.
—Claro, claro. Para simplificar: en el núcleo del Sol tiene lugar una serie de reacciones nucleares como la anterior, esa en la que se produce un núcleo de deuterio a partir de dos protones. Al final de esta cadena de reacciones nucleares, cuatro protones se juntan y se crea un núcleo de Helio 4.
—¿Y qué? —intento que no se note que me estoy poniendo impaciente.
—Resulta que la masa de este núcleo de He es menor que la de los cuatro protones. Se ha perdido masa por el camino... ¿cómo puede ser? ¿Te suena un tal Einstein?
—¡¡Por supuesto!!
—¿Y la ecuación E = m c2? La masa no se crea ni se destruye...
—... ¡sino que se convierte en energía! —termino la frase a mi manera—. La diferencia de masa se transforma en energía...
—... y por eso brilla el Sol—remata Montse.
Montse continúa explicándome cómo la energía que se genera en el núcleo solar gracias a estas reacciones de fusión realiza un lento camino hacia la superficie.
—A unos 470.000 km del centro, la energía empieza a transportarse hacia arriba gracias a la convección...
—¡Ah, eso me lo sé!—la interrumpo—. Es lo mismo que pasa cuando ponemos... cuando poníamos... la calefacción en marcha. Al calentarse el aire que está en contacto con un radiador, su densidad decrece y el aire sube hacia arriba. Entra en contacto con aire más frío y le cede calor. Entonces se enfría, se vuelve más denso y vuelve a bajar.
—¡Muy bien! —Montse me guiña un ojo—. Pues ahora vas a tener que fiarte de mí otra vez. El gas está casi completamente ionizado: es una "sopa" de electrones e iones (protones, He+2, etc.). Es lo que se llama un plasma.
—¿Cómo el plasma de la sangre? —vuelvo a interrumpir.
—Ja, ja, nooo. Es solo el mismo nombre, pero no tienen nada que ver —y continúa—. Así que tenemos cargas y movimientos convectivos, vamos, cargas en movimiento. Ya sabes que una carga en movimiento produce un campo magnético, por lo que de esta manera se crean campos magnéticos en el interior del Sol.
—Me cuesta seguirte —le digo.
—Me lo imagino, no es fácil. Te dije que te tenías que fiar de mí. El mecanismo por el que se crean estos campos magnéticos se llama dinamo. También tiene lugar en la Tierra y por eso puedes emplear una brújula cuando vas de excursión.
—Eso sí lo entiendo —sonrío—. La aguja de la brújula se alinea con la dirección del campo magnético.
—Bien, entonces recuerda que en el Universo nada es gratis: para crear campos magnéticos es necesario "gastar" energía. La dinamo solar convierte energía cinética de la convección en energía potencial magnética.
—¿Qué me estás contando? —digo, enarcando las cejas—. Me suena a chino.
—Muy sencillo: si alzas ese libro de ahí, le estás dando energía potencial gravitatoria, ¿no? Si después sueltas el libro, esa energía se convierte en cinética y el libro cae. Con los campos magnéticos pasa exactamente lo mismo: pueden almacenar energía potencial (magnética, claro) y luego la pueden devolver como energía cinética. ¡Y con esto, casi hemos llegado a la GTS!
Justo en este momento la vela se apaga y tenemos que usar una de las pocas cerillas que quedan para volver a encenderla. Montse me propone tomarnos un descanso, pero, aunque me cueste reconocerlo, quiero que me siga contando su historieta. Y la convenzo. Me explica que los campos magnéticos que se "fabrican" en el interior del Sol suben hacia la superficie como un corcho colocado bajo el agua.
—Sí, esa es otra cosa en la que te tienes que fiar de mí.
—De acuerdo, te creo. ¿Y después?
—Después... sabes que un imán tiene un polo norte y un polo sur, ¿verdad? ¿Y qué lo mismo pasa con la Tierra?
—Pues claro.
—Pues la superficie del Sol, que se llama fotosfera, está llena de polos magnéticos norte y sur. Por todos lados.
Montse rebusca en una carpeta y saca una fotografía con un círculo gris cubierto de manchas blancas y negras (Fig. 1a).
—Mira, esto es un magnetograma de la superficie del Sol —prosigue—. Los campos magnéticos más intensos corresponden a los colores blanco (polo norte) y negro (polo sur). En la superficie solar una brújula ¡podría apuntar en cualquier dirección!
—Vaya, pues sí que es curioso.
—Y aún hay más: estos campos magnéticos intensos impiden los movimientos convectivos, es decir, no permiten que la convección lleve la energía hacia arriba. Por eso el gas fotosférico está más frío en las zonas blancas y negras del magnetograma —Montse rebusca de nuevo en la carpeta y saca otra fotografía, con un disco anaranjado (Fig. 1b)—. Ves, esta es una imagen de la fotosfera, como la veríamos a simple vista con unas gafas especiales para eclipses. Y las manchas negras son manchas solares.
—Galileo ya observaba manchas solares con un telescopio, ¿verdad?
—Efectivamente. Pero Galileo no podía ver la atmósfera del Sol.
Sin embargo, ahora la podemos estudiar gracias a telescopios que captan la luz ultravioleta. Mira —me dice mientras hace aparecer dos fotos más—. Aquí (Fig. 1c) puedes ver que encima de los campos magnéticos intensos, o sea, encima de las manchas solares, la atmósfera solar es muy brillante; estas zonas brillantes se llaman regiones activas y son las discotecas de la atmósfera del Sol, dónde pasan cosas, dónde está la marcha.

Fig. 1. (a) Magnetograma de la superficie solar (fotosfera). (b) Imagen de la fotosfera. (c) Imagen de la atmósfera solar en la longitud de onda de 21.1 nm, que muestra el plasma de la atmósfera solar a temperaturas cercanas a 2×106 K. (d) Ampliación de la parte de la Fig. 1c dentro del recuadro blanco. © NASA/SDO.
A Montse le gusta hacer este tipo de bromas. ¿Qué le vamos a hacer?
—Si miras esta ampliación (Fig. 1d) verás que esta región activa —y señala a la que está en la parte de arriba de la foto— tiene un montón de arcos (les llamamos bucles) que conectan un polo norte y un polo sur —y ahora señala a las correspondientes manchas, blanca y negra, del magnetograma (Fig. 1a).
—Esto me suena familiar —intervengo—. Pero no sé a qué me recuerda.
—Quizás al experimento que consiste en tirar limaduras de hierro sobre un papel colocado encima de un imán. Las limaduras se alinean a lo largo del campo magnético.
—Entonces, ¿el gas de la atmósfera solar se alinea a lo largo del campo magnético?
—¡Exactamente!
—¿Y tiene esto algo que ver con la GTS?
—Sí, lo has adivinado. Esta otra región activa —señala la que está abajo a la derecha (Fig. 1d)— tiene una pinta rara, ¿no te parece? Esa traza blanca vertical nos dice que el detector está recibiendo demasiada luz.
—¿Y por qué emite tanta luz esta región activa?
—Porque se ha acumulado tanto campo magnético en la misma zona que la configuración es inestable. Es como si empujases esa caja que está encima de la mesa: al llegar al borde la caja caerá al suelo. Con la consiguiente conversión de energía potencial (gravitatoria) en cinética. Lo mismo pasa en esta región activa: se ha almacenado una gran cantidad de energía potencial (magnética) y en un momento dado se transforma en energía cinética.
—Creo que lo entiendo.
—Esto se conoce como fulguración. Es una explosión gigantesca que puede expulsar una enorme cantidad de materia de la atmósfera solar hacia el medio interplanetario. Y si la Tierra está en el camino de esta materia, entonces ¡empiezan los fuegos artificiales! Estas cargas que llegan desde el Sol pueden inducir corrientes en muchos de nuestros aparatos electrónicos y, lo que es peor, en las líneas de distribución eléctrica...
—¿La GTS? —¡¡al fin!!, pienso.
—¡Eso es! Las fulguraciones normales (puede haber incluso unas cuantas en un día) solo provocan auroras boreales y australes. Las más energéticas pueden afectar a las naves espaciales y obligar a modificar las rutas de avión que sobrevuelan el ártico.
—Eso no es muy impresionante...
—Cierto, pero en 1859, por ejemplo, hubo una fulguración tan energética que las líneas del telégrafo se llenaron de electrones perversos corriendo alegremente. A finales del siglo XX ya sabíamos que una fulguración como esa nos pondría en apuros muy serios, porque dependemos, mejor dicho, dependíamos muchísimo de la electrónica.
—¿Y no se hizo nada para prevenir un suceso así?
—Sí, pero no fue suficiente. Al lado de la GTS, el suceso de 1859 fue como una brisa comparada con un huracán. Los electrones perversos que se "colaron" en las líneas de distribución eléctrica llegaron a las centrales eléctricas y "fundieron" la mayoría de transformadores.
La vela se apaga de nuevo. Es tarde y hace frío, así que decidimos dejarlo por hoy.
F I N
Es difícil asegurar que la ficción anterior no vaya a suceder, aunque es poco probable porque las fulguraciones solares tan extremas ocurren muy raramente. Se estima que una fulguración como la de 1859 puede provocar daños por valor de varios billones de $ solo en los EUA y que la economía tardaría varios años en volver a la normalidad. A parte de la GTS, el resto del texto está basado en datos reales, aunque en alguna ocasión he tenido que simplificar la explicación para que resulte más comprensible.
Si piensas que estudiar el Sol puede ser divertido, ¡apúntate a un grado en Física!
Notas:
Las imágenes están tomadas de la web del satélite SDO (https://sdo.gsfc.nasa.gov/).
Para ver el desarrollo de la fulguración de la Fig. 1 podemos descargar la película de: https://sdo.gsfc.nasa.gov/gallery/main/item/837
Ramón Oliver
Doctor en Física
Catedrático de Universidad, Universitat de les Illes Balears
Mi vocación por la Física se fraguó hacia los 17 años, cuando la curiosidad me llevaba a husmear en los últimos capítulos de los libros de texto, aquellos que nunca da tiempo a ver en clase, en especial los de Física y de Filosofía. Allí me topé con fenómenos como el extraño comportamiento de los electrones en los átomos, o maravillas como la idea del espacio-tiempo y su curvatura como explicación de la fuerza de la gravedad. Estos "descubrimientos" de juventud me fascinaron y me produjeron una atracción irresistible. En aquella época sin internet y casi sin acceso a material de divulgación científica, no sabía poner nombre a esta vocación, pero el tiempo se encargó de mostrarme que lo que quería, aunque aún no lo supiera, es ser Físico Teórico.
¿Qué es la Física Teórica y para qué sirve?
Hoy el término "Física Teórica" es mucho más conocido, a través de grandes figuras mediáticas como Stephen Hawking o de su incorporación a la cultura popular con personajes como Sheldon Cooper de la serie "The Big Bang Theory". Pero ¿qué es en realidad la Física Teórica?
La Física Teórica es la rama de la Física que propone modelos teóricos para los fenómenos fundamentales observados en la naturaleza. Por "fundamentales" podemos entender los que se manifiestan en las situaciones más extremas de la materia y la energía, y que proporcionan respuestas científicas a las preguntas fundamentales que se planeta el ser humano sobre el mundo que le rodea.
Un ejemplo es lo infinitamente pequeño, donde se estudian las leyes que rigen el comportamiento de las partículas elementales a las más altas energías accesibles en los colisionadores de partículas como el LHC del CERN en Ginebra. Éstas incluyen los electrones, los quarks que componen protones y neutrones, las partículas que median sus interacciones, el bosón de Higgs, etc. Es decir, las que componen el Modelo Estándar de Partículas Elementales, la teoría que describe el frenesí cuántico, que constituye nuestra respuesta científica actual a la pregunta "¿de qué están hechas las cosas?"
Otro ejemplo es el de lo infinitamente grande, el estudio del Universo como un todo, como respuesta a las preguntas "¿cómo es el Universo y de qué está compuesto?" "¿cómo empezó?" y "¿cuál es su destino final?".

Fig. 1. La Física Teórica abarca las principales incógnitas del Universo, desde lo infinitamente pequeño a lo infinitamente grande.
La Cosmología estudia la estructura del Universo, su composición, y su origen como un plasma primigenio a las más altas temperaturas y lanzado a una expansión desbocada. Esta expansión, fruto de la dinámica del espacio-tiempo descrita en el marco teórico de la Relatividad General, no solo determina la historia pasada del Universo, sino su destino último, en una expansión eternamente acelerada, alimentada por una energía de vacío, que denominamos energía oscura, pero cuya naturaleza está aún por determinar.
Un ejemplo final es la frontera de la complejidad, en la que la Física Teórica estudia la aparición de nuevos fenómenos emergentes en sistemas de muchos componentes, nuevos modos de comportamiento de la materia y la energía que no están manifiestos en la descripción microscópica del sistema.
Esta vibrante rama de la Física se encuentra en la interface de otras áreas, como la Física de la Materia Condensada y la Información Cuántica.
¿Y el experimento?
Gran parte de estas exploraciones es experimental y observacional, en tanto que en Física, como ciencia empírica, la última palabra la tiene el experimento. Pero de forma complementaria, la Física Teórica permite llevar más allá las fronteras del pensamiento científico, y plantear preguntas cuyas respuestas solo podrán ser confirmadas experimentalmente en un futuro. De esta manera, la Física Teórica no solo construye la interpretación teórica de fenómenos observados, sino que sirve de guía en la exploración futura de la naturaleza.
Esto ha sucedido en el pasado reciente, por ejemplo con el mecanismo de Higgs, que permaneció durante décadas como un modelo teórico propuesto como explicación de la generación de masas para las partículas elementales del Modelo Estándar, y una guía en la propuesta de nuevos y más potentes aceleradores de partículas. El descubrimiento del bosón de Higgs en los experimentos ATLAS y CMS del CERN confirma la realidad física de este fenómeno, completando una preciosa historia de colaboración entre Física Teórica y Física Experimental durante los últimos 50 años.
De forma similar, la reciente detección directa por la colaboración LIGO (y posteriormente con VIRGO) de ondas gravitacionales en procesos de fusión de sistemas binarios de agujeros negros, y de estrellas de neutrones, culmina con una fascinante confirmación observacional una predicción teórica centenaria de la Relatividad General. Y cuya importancia radica en que abre una revolucionaria nueva ventana al Universo con la promesa de numerosas sorpresas teóricas y observacionales en los próximos años.
Se espera que de igual modo, las fronteras que la Física Teórica explora hoy día guíen el desarrollo de nuevos experimentos y métodos de medición que permitan avanzar en el futuro conocimiento de la naturaleza. Por ejemplo, propuestas como el origen del Universo en una etapa de inflación cósmica en la primera fracción de segundo; o cuestiones que hoy parecen remotas especulaciones, como la descripción de gravedad cuántica en términos de teoría de cuerdas, o el estudio de los agujeros negros a nivel cuántico a través de modelos teóricos como las dualidades holográficas. Estas construcciones teóricas pueden quizás contener las claves que marquen nuestra concepción del Universo y la realidad física dentro de algunas décadas.
¿Y las aplicaciones prácticas?
La Ciencia tiene una indudable faceta de aplicaciones prácticas, claramente manifiesta en nuestra vida cotidiana, desde el ámbito más individual como el del electromagnetismo subyacente en el funcionamiento del microondas que nos calienta el café por la mañana, hasta el más colectivo y social de la electrónica y la tecnología de comunicaciones que nos vinculan a través de dispositivos digitales y canalizan nuestras conversaciones y las corrientes de opinión de nuestra sociedad.
Esta faceta práctica parece ausente en el campo de la Física Teórica. Y en el fondo, así es... ¡y así debe ser! La Física Teórica se nutre de la curiosidad pura del ser humano, y su objetivo es y debe ser generar el conocimiento para satisfacerla. No obstante, también es correcto que incluso desarrollos teóricos extremadamente abstractos han sido fundamentales en el desarrollo de nuevas tecnologías y aplicaciones prácticas. El estudio de la Física Cuántica a principios del siglo XX constituía un área de interés meramente académico; pero su impacto en la comprensión fundamental de las propiedades químicas de los elementos, de la dinámica de moléculas complejas incluidas las orgánicas, o de las propiedades de nuevos materiales como los semiconductores, han implicado revoluciones en las aplicaciones prácticas de la Química, la Biomedicina, o en el desarrollo de nuevas disciplinas como la Computación y las Nuevas Tecnologías. Igualmente, el conocimiento de las sutiles correcciones a la gravedad de Newton dictadas por la Relatividad General de Einstein son esenciales para el correcto funcionamiento de tecnologías muy precisas, pero cotidianas, como los navegadores GPS.
Lo que la Historia recomienda, por tanto, es evitar puntos de vista cortoplacistas en lo que respecta a la Física Teórica, y promover su investigación en tanto que motivada por la curiosidad pura, con la certeza de que la aplicación práctica de los nuevos conocimientos adquiridos terminará llevándose a cabo de maneras imposibles de anticipar hoy día. Podemos plantearnos esta investigación, por tanto, como un acto de generosidad para las generaciones venideras, que esperamos plasmen en herramientas útiles muchos de los resultados que hoy nos parecen tan alejados de la vida cotidiana.
Un poco de mi investigación...
Retomando mi relato biográfico inicial, mi carrera tomó el camino más común hacia el mundo de la investigación: estudios de licenciatura, iniciación en la investigación durante los años de preparación de mi tesis doctoral y diversas estancias postdoctorales de varios años en centros de investigación extranjeros hasta incorporarme a mi centro actual, el Instituto de Física Teórica en Madrid. Una travesía no siempre exenta de complicaciones, pero en la que la pasión por la Física ha sido un motor constante.
A lo largo de estos años, mi campo de investigación se orientó y especializó hacia el estudio de la teoría de cuerdas, especialmente el problema de cómo encajar la Física de Partículas conocida, el Modelo Estándar, en este marco teórico. La teoría de cuerdas proporciona una descripción en la que la gravedad, así como el resto de interacciones fundamentales, quedan descritas de forma compatible con las leyes de la Física Cuántica. Parte de la hipótesis de que las partículas elementales no son entes puntuales, sino objetos extensos unidimensionales (cuerdas) de tamaño tan extraordinariamente pequeño que su carácter extenso no se manifiesta en los experimentos actuales. Sin embargo, la teoría lleva a modificaciones brutales de la Física, como la necesidad de que existan dimensiones espaciales adicionales, igualmente de tamaño tan minúsculo que escapan cualquier intento de detección directa. A pesar de ello, la geometría y otras propiedades del espacio interno definido por estas dimensiones extra son esenciales en determinar el contenido preciso de partículas elementales e interacciones fundamentales que se observarían a las escalas ordinarias de Física de Partículas. Por tanto es una cuestión fundamental el análisis de las propiedades de estos espacios internos que producen una Física de Partículas que corresponda al Modelo Estándar.
El estudio de este área de la Física Teórica me resulta enormemente divertido y satisfactorio, porque me permite visualizar las partículas ordinarias y sus propiedades como pistas en un mapa geográfico de estos espacios interiores que estoy seguro ocultan más de un tesoro (científico).
A modo de conclusión
La Física Teórica es un área de investigación extremadamente interdisciplinar (Fig. 1) y que permite acceder a las cuestiones más fundamentales del Universo, y describir la naturaleza en términos de leyes de enorme potencia conceptual y belleza matemática. Si te interesan las grandes incógnitas del Universo, su origen, su destino final, la materia y energía que lo componen, y los principios fundamentales de su dinámica, es muy posible que ¡tú también quieras dedicarte a la Física Teórica!
Ángel M. Uranga
Doctor en Física Teórica
Profesor de Investigación, Instituto de Física Teórica UAM-CSIC
¿Por qué ser científico?
“¿Mamá, por qué veo la luz con tantos colores en ese espejo?” “¿Y por qué cuando salto siempre caigo al suelo?” Éstas son sólo dos de las cientos de preguntas que cualquier niño/a hace para saciar su curiosidad. Desafortunadamente, esta inocente curiosidad hacia los fenómenos naturales que nos rodean se va perdiendo a medida que crecemos. Pero no en el caso del científico.
En efecto, la característica esencial de un científico es su interés, en muchas ocasiones rozando la obsesión, sobre el funcionamiento de la Naturaleza. En algunos casos, tal interés se centra en una única rama de la ciencia (matemáticas, química, biología,…); en otros, por su parte, el científico cuestiona aspectos tan variados como las mareas, la fotosíntesis o la evolución de las especies. En los albores del pensamiento científico, allá en la época de los presocráticos hace unos veintiséis siglos, los pocos que se preocupaban por la Naturaleza, los filósofos, tenían un rango de intereses bastante amplio. Tras el letargo intelectual en que se sumió Europa durante unos diez siglos, el Renacimiento impulsó el desarrollo de la filosofía natural y la tecnología, culminando en la Revolución Industrial. A partir del s. XIX, la filosofía natural dejó paso a la ciencia moderna, que se especializó en diversas disciplinas debido a la acumulación del conocimiento científico.
Una de estas ramas de la ciencia, quizás la segunda más antigua por detrás de la astronomía, es la física. No es nada fácil definir qué estudia la física, ya que las teorías modernas han roto viejas fronteras entre distintas ciencias. A modo de ejemplo, ¡toda la química se explica mediante teorías físicas! Y la astronomía, en su día una ciencia independiente, no es más que la aplicación de la física a los cuerpos celestes. Incluso la biología, tradicionalmente totalmente separada de la física, es susceptible de modelos teóricos aproximados basados en los mismos conceptos de la propia física. Así, podemos decir que la física estudia… ¡todos los procesos naturales!
Física: experimental vs teórica.
Conviene aclarar la diferencia entre física experimental y física teórica. Para ello, es más útil comentar brevemente un par de ejemplos.
Astronomía.
Los orígenes de la astronomía se remontan a la época sumeria de la antigua Mesopotamia, hace unos cinco milenios, que figuran en los catálogos de estrellas de la antigua Babilonia, hace unos 3200 años. El objetivo era la ayuda en navegación y la confección de calendarios para organizar la retahíla de festividades religiosas. Su trabajo consistía en realizar observaciones, sin importarles la causa de los movimientos celestes. Sin apenas cambios significativos, las tablas astronómicas babilónicas llegaron a manos de Ptolomeo en el s. II, con las que creó su modelo geocéntrico del Universo (esto es, el Sol, los planetas desde Mercurio hasta Saturno y las estrellas fijas). Tuvieron que pasar unos catorce siglos hasta que Copérnico desarrollase su modelo heliocéntrico, el cual inspiró a Kepler a hallar las leyes del movimiento planetario.
Kepler se basó en las modernas observaciones de Brahe, quien mejoró notablemente la precisión de los aparatos astronómicos. Gracias a ello, Kepler dispuso de una ingente cantidad de datos para tratar de encontrar la causa del movimiento celeste. Aquí es donde entra en escena su condición de teórico. Pasó varios años calculando cómo debían de ser las órbitas de los planetas para que concordasen con los datos de Brahe. En particular, se obsesionó con el díscolo Marte, cuya órbita exhibía un movimiento retrógrado del planeta. Al final, tras un esfuerzo mental extenuante, logró enunciar sus famosas leyes. Así, tenemos:
-Observacional: Las tablas astronómicas de los babilonios, primero, y de Brahe, después, que sólo se preocupaban por su uso, sin entrar en las causas de los movimientos observados.
-Teórico: Los modelos de Ptolomeo y Copérnico, primero, a partir de los datos babilónicos, y de Kepler, después, tomando las observaciones de Brahe. Los tres, Ptolomeo, Copérnico y Kepler sí tratan de explicar los movimientos celestes; otra cosa es que hoy día consideremos que el último, el modelo de Kepler, sea el mejor.
Electricidad, magnetismo y luz.
El segundo ejemplo sobre la diferencia entre experimentación y teoría tiene como temas la electricidad, el magnetismo y la luz. Antes de ello, conviene aclarar la diferencia entre observar y experimentar. Básicamente:
-La observación es un acto pasivo, donde la persona se limita a ver qué pasa con un proceso natural dado. El movimiento planetario es un ejemplo claro. No podemos cambiar las posiciones o velocidades de los cuerpos celestes para ver qué ocurriría si sus valores fuesen distintos. Son los que son.
-La experimentación, por su parte, es una tarea activa del experimentador. Él o ella tienen la libertad de establecer las condiciones iniciales del experimento y de jugar con ellas para analizar cómo influyen tales cambios en la evolución del fenómeno natural. Un ejemplo sencillo es jugar con un conjunto de lentes de diferente tamaño y curvatura, así como con la distancia entre ellas y el foco de luz. El experimentador controla las condiciones del proceso y puede obtener imágenes con distintas características (color, tamaño, derecha o invertida, etc.).
Volvamos a la historia de la electricidad, el magnetismo y la luz. A riesgo de trivializar en exceso el desarrollo histórico, nuestros protagonistas serán el inglés Michael Faraday y el escocés James Clerk Maxwell.
Durante el siglo XVIII y primera mitad del XIX, numerosos científicos, culminando con Faraday, habían realizado toda una serie de experimentos sobre electricidad y magnetismo que dejaban claro que existía alguna relación entre ambos fenómenos. Enfaticemos que estamos hablando de experimentar, no observar. Por tanto, estos científicos controlaban las condiciones de sus experimentos y las modificaban convenientemente para estudiar los cambios. Además, algo muy importante, estos físicos, al contrario que los astrónomos (babilonios o griegos), sí se interesaban por las causas de los procesos físicos. Faraday sabía perfectamente cuándo una corriente eléctrica generaba magnetismo o, al revés, cuándo un imán daba lugar a una corriente eléctrica. Lo que ignoraba era la relación exacta entre electricidad y magnetismo.
El reto era precisamente elucidar tal relación. Partiendo de un riguroso estudio de los descubrimientos de Faraday, Maxwell se propuso hallar una teoría que unificase la electricidad y el magnetismo, es decir, un conjunto de ecuaciones que describiesen todos los hallazgos experimentales sobre los procesos electromagnéticos. Al igual que Kepler, se sumergió en el problema durante varios años (en tres etapas, ¡eso sí!). El resultado, cuatro ecuaciones que, como el genial Einstein dijo, supusieron un antes y un después en la historia de la física. Porque estas ecuaciones no sólo unificaron la electricidad y el magnetismo: la luz, el objeto de estudio de la óptica durante los dos siglos anteriores, ¡resulta que no es más que una manifestación del electromagnetismo! Así, de una tacada, Maxwell logró explicar de manera unificada fenómenos tan dispares como los rayos, el funcionamiento de la brújula o el arcoíris.

Fig. 1. Las figuras muestran la teoría de Maxwell: arriba, el espectro electromagnético barriendo longitudes de onda y frecuencia/energía; abajo, las componentes eléctrica y magnética de una onda electromagnética genérica (la parte magnética no se ilustra arriba, pero iría perpendicular al plano de la pantalla, como se indica abajo).
Por tanto, podemos resumir la diferencia entre experimentación y teoría:
-El físico experimental se centra en realizar meticulosos experimentos para comprobar una hipótesis. Tales experimentos generan una enorme cantidad de datos a analizar. A continuación, propone modelos para obtener una explicación cualitativa de los resultados. Además, puede emplear sencillas ecuaciones para lograr una estimación cuantitativa de los datos. En general, los experimentos se refieren a un área concreta de la física (en el ejemplo, electricidad y magnetismo).
-El físico teórico, por su parte, explica resultados experimentales mediante modelos matemáticos más avanzados que los modelos usados por los experimentales, lo que le permite una mayor descripción cuantitativa. Y si es bueno, el teórico también unificará, en un mismo conjunto de ecuaciones, procesos que aparentemente no tienen una misma causa. En nuestro caso, Maxwell creó el electromagnetismo. Finalmente, una buena teoría debe predecir nuevos fenómenos que nadie haya contemplado antes (ya sean físicos experimentales o teóricos). Maxwell predijo que la luz no es sino una manifestación del electromagnetismo, algo que se verificó experimentalmente una década después de su muerte. Así, tres ramas de la física que inicialmente no guardaban conexión entre ellas, electricidad, magnetismo y óptica, se fusionaban en una sola.
Lo que me llevó a ser físico teórico.
El motivo por el que una persona decide (porque tiene la opción de elegir) ser científico/a es necesariamente una cuestión muy personal. En mi caso, me decanté por la física precisamente por el hecho que hemos comentado arriba, a saber, que sus ideas y métodos se pueden aplicar, en principio, a cualquier fenómeno natural. En otras palabras, la física es la ciencia más general de todas.
¿Y por qué físico teórico? Como hemos dicho, una teoría busca relacionar procesos aparentemente distintos. Esto requiere de abstracción, es decir, la capacidad de hallar patrones comunes en diferentes objetos (llamar ‘ ’ a peras, en un problema, y a monedas, en otro, nos permite usar las reglas de las ecuaciones en ambos casos). Esta abstracción exige matemáticas cada vez más avanzadas a medida que progresa la física. Y, bueno, ¡me encantan las mates! Así que, en resumen, soy físico teórico porque en ello convergen dos pasiones: i) unificar fenómenos naturales y ii) las matemáticas.
’ a peras, en un problema, y a monedas, en otro, nos permite usar las reglas de las ecuaciones en ambos casos). Esta abstracción exige matemáticas cada vez más avanzadas a medida que progresa la física. Y, bueno, ¡me encantan las mates! Así que, en resumen, soy físico teórico porque en ello convergen dos pasiones: i) unificar fenómenos naturales y ii) las matemáticas.
Para concluir, quisiera resaltar las dos cualidades más valiosas de todo científico: la honestidad y la pasión. Puede parecer algo sin mucha importancia. Permitidme contar una historia real que me ha servido de inspiración.
El físico inglés Julian Barbour es una persona peculiar. Tras su doctorado, se dio cuenta que, honestamente, no entendía qué era eso que la gente llamaba “tiempo”. Sabiendo que este tipo de cuestiones tan “filosóficas” no están de moda en los departamentos de física, decidió no seguir el camino normal de un investigador. Durante toda su vida, trabajando como traductor de artículos científicos del ruso al inglés, ha estado obsesionado con desarrollar una teoría física despojada del concepto de tiempo. Ésta es su gran pasión.
Tuve el privilegio, en mis años de doctorado, de pasar un fin de semana en su casa rural cerca de Oxford. Me di cuenta que mi situación era muy similar a la suya cuando tenía mi edad. Desde entonces, procuro seguir el camino por el que me conduce mi pasión, la gravitación cuántica, aunque ello signifique tener que buscar un trabajo no directamente relacionado, pero que, al menos, me permita la mayor libertad posible.
La ciencia es un largo viaje hacia la búsqueda de territorios inexplorados.
Pedro Naranjo
Doctor en Física
Geometric Energy Corporation, Calgary, Alberta, Canadá
Cuando era niño, en el preescolar, le pregunté a mi papá si había alguna profesión que estudiara el cielo y me dijo que los astrónomos hacían eso. Así que decidí que, de grande, iba a ser astrónomo. Después quise dedicarme al dibujo y después a la música. Cuando me tocó tomar la decisión, casi me hago músico pero, pensando que música podría tocar toda mi vida (aún haciéndolo mal), en cambio hacer física parecía necesario tener cierta preparación, decidí (con mucho trabajo y casi cerrando los ojos para no ver lo que estaba dejando atrás), entrar a la carrera de física. ¿Y la astronomía? Bueno, en aquellos tiempos descubrí que para ser astrónomo o astrofísico, era necesario tener primero el grado de físico y luego el posgrado en astronomía. Durante mis estudios me enamoré de las matemáticas formales, su lógica inquebrantable, su pensamiento abstracto de las ideas, el ingenio necesario para resolver un problema con el puro uso de la mente y las reglas lógicas. Al mismo tiempo, me fui enamorando de la física teórica, la cual utiliza magníficamente el lenguaje abstracto de las matemáticas para describir el mundo. La astronomía fue siendo relegada a medida que avanzaba en mis estudios. La Cosmología, la Teoría de Relatividad, la Mecánica Cuántica, la Teoría Cuántica de Campos, la Teoría de Cuerdas... ¡todo me llamaba a estudiarlas y dedicarme a eso! Pero, claro, sin dejar de lado las matemáticas, entre más matemáticas y más abstracto, mejor. Así es como, al final de mis estudios de grado descubrí un formalismo matemático nuevo que estaba en desarrollo en la física: la Cuantización Topológica. El nombre en sí dice mucho y no dice nada pero podemos remarcar lo obvio: la palabra "cuantización" tiene que ver con la física cuántica (es decir, el estudio de los fenómenos del mundo subatómico: átomos, protones, neutrones, electrones, quarks, gluones,…), y la palabra "topológica" tiene que ver con el área de las matemáticas que estudia las formas distintas del espacio (por ejemplo, la diferencia entre una dona y una pelota: una tiene un agujero y la otra no), pero eso no es todo, lo que no dice el nombre "Cuantización Topológica", es que es una estructura matemática (topológica) que se usa para estudiar comportamientos cuánticos (propiedades que se ven en el mundo subatómico) de casi ¡cualquier sistema físico! (sistemas gravitacionales, teoría de cuerdas, agujeros negros, etc.). De esta manera abandoné la astronomía y me convertí en físico-matemático.
¿Qué es un físico-matemático?
Es un físico teórico; es una persona que trabaja haciendo modelos de lo que se observa en la naturaleza, pero donde esos modelos son matemáticos. Por ejemplo, en la Teoría de Relatividad General existen los agujeros negros, esas masas enormes contenidas en una región muy pequeña que son capaces de "tragar" la luz que les llega y no la dejan escapar debido a la enorme gravedad que hay cerca de ellos. Como físico-matemático, me construí (junto a otros dos científicos) un modelo geométrico abstracto que "codifica" en una superficie de sólo dos dimensiones: largo y ancho, por ejemplo (¡la Teoría de Relatividad usa cuatro dimensiones!) toda la información de un tipo de agujeros negros (hay muchos tipos), de modo que es más fácil investigar algunas propiedades físicas de los agujeros negros usando este modelo geométrico.
¿En qué áreas de investigación puede trabajar un físico-matemático?
Casi en cualquiera. Yo, por ejemplo, he trabajado en mecánica cuántica, en teoría de cuerdas, en termodinámica, en gravitación, en relatividad, incluso estuve trabajando en ¡modelar papel! Tengamos en cuenta que el lenguaje natural de la física es la matemática, por lo que si lo hablas bien puedes platicar con investigadores de distintas áreas en física. Pero, por lo mismo, también puede uno trabajar en investigación puramente matemática, pero eso depende de los gustos de investigación de cada uno, lo importante es lo flexible que llega a ser uno para involucrarse en distintas áreas, lo cual, dicho sea de paso, no es común que ocurra con las otras disciplinas en física.
¿Qué desventajas tiene ser físico-matemático?
Un físico-matemático es un buen físico teórico en general pero no es especialista en ningún área de la física en particular, lo cual implica un montón de estudio y de trabajo para entender el área particular en la que se que quiere trabajar en ese momento o en colaboraciones con otros investigadores. Lo puse como desventaja, lo sé, aunque realmente me gusta tanto que para mí, aprender más y más cada vez, me parece más una ventaja aunque es cierto que cuesta más horas de trabajo y estudio en cada paso que se da.
¿Quién puede ser un físico-matemático?
Cualquiera que encuentre en su interior un gusto honesto por las matemáticas y por entender los fenómenos de la naturaleza. La carrera de física, y la labor de investigación misma, no está hecha por los genios, en realidad, está hecha por personas normales cuya cosa en común es su amor por su trabajo. Si hay disposición a entender el mundo que observamos, por difícil que parezca hacerlo, entonces hay carácter para ser físico, lo de matemático se meterá en la tripa posteriormente, si fuera el caso.
¿Qué hay que estudiar para ser físico-matemático?
Se puede empezar estudiando la carrera de física (con perfil teórico) o la de matemáticas. Posteriormente hay que hacer un posgrado y obtener el doctorado, lo cual es necesario para dedicarse a la investigación en las universidades. Ahora una advertencia, en mi experiencia, es más común que un físico haga física-matemática que un matemático, aunque si uno tiene la pasión, cualquiera lo puede hacer.
¿Dónde trabaja un físico-matemático?
En su mayoría, en las universidades del mundo. Aunque, como físico-matemático es relativamente fácil dedicarse a la industria o a la matemática aplicada, la labor de investigación libre se realiza casi exclusivamente en las universidades.
Comentarios finales.
No es necesario ser un físico-matemático para hacer cosas en física-matemática, de hecho, muchos investigadores teóricos han hecho proyectos muy interesantes que se consideran de física-matemática, por lo que es posible dedicarse a cualquier área de la física y trabajar paralelamente en física-matemática, sin embargo, algunos tenemos ese amor por trabajar siempre en modelos de esta área y es así como uno termina dedicado de tiempo completo a ésta área.
He intentado hacer notar que para dedicarse a la ciencia, sólo hay que tener el gusto y no tener miedo al fracaso, al final, sólo hay que dedicarle tiempo y seguir aprendiendo. Al final del día, los científicos hacemos lo que más nos gusta y por eso, todo el tiempo que le dedicamos, es más un tiempo de jugar que de "trabajo". Sin dejar de mencionar que la ciencia es una disciplina altamente colaborativa en la que uno conoce muchas personas y trabaja con personas diferentes y en varias cosas.
Así que, si te gusta la ciencia, pruébala. Si te enamora, no tengas miedo y dedícate a ella, si no lo hace, ¡corre!, porque sólo enamorado de la ciencia se puede vivir con ella.
Gustavo Alfredo Arciniega Durán
Doctor en Ciencias (Física), por la Universidad Nacional Autónoma de México.
Investigador postdoctoral en la Universidad de Santiago de Compostela, España.
Física, una palabra que inspira tanto y a la vez tan poco. Todos hemos oído hablar de esta ciencia desde que somos pequeños pero, a no ser que se tenga a algún físico en el entorno, no sabemos bien qué pensar. Suena difícil, complejo, misterioso y, a la vez, majestuoso. Cuando vemos películas como por ejemplo Interestellar, nos despierta un interés en querer entender si es posible lo que vemos o ciencia ficción, surgen debates entre amigos e incluso muchos buscan información en internet. Nace un interés por saber lo que hay detrás, o lo que es lo mismo, la física.
La física que estudiamos en el instituto me resultaba bastante aburrida, un poco lejos de lo que me inspiraban los documentales de galaxias, las visitas al planetario, o videos de YouTube sobre agujeros negros. Ahora entiendo que para entender todo eso, es necesaria la base que nos explican en el colegio y, no menos importante, un buen profesor que nos motive y nos relacione esa base físico-matemática con las más punteras investigaciones.
Yo tuve mucha suerte al tener un excelente profesor. En las clases nos enseñaba el temario del curso, nos explicaba noticias sobre ciencia, los premios Nobel y, además, a ser unas personas críticas con nuestro entorno y con nosotros mismos. No se puede saber qué pasaría si cambiamos algo de nuestro pasado, pero a lo mejor no estaría escribiendo estas palabras ahora si no hubiera sido por tener aquel profesor. Si no tenéis dicha suerte, buscadla. Pero no os dejéis influenciar por un mal profesor, orientador, amigo o familiar.
Personalmente se me recomendó que no estudiara física. "Es una carrera muy complicada y tú sueles suspender matemáticas, física y química" – solían decirme. Es cierto que suspendía, pero aquellos que lo decían no se preocupaban por saber por qué lo hacía. Tenía varias razones, no estudiaba lo suficiente, los nervios me hacían equivocarme con frecuencia y no tenía un entorno favorable para estudiar como la mayoría de mis compañeros. Pero entendía los conceptos y tenía claro que era lo que me gustaba aprender, física. Así que ignoré todos esos comentarios y tuve presente la cita de Santiago Ramón y Cajal: "Todo hombre puede ser, si se lo propone, escultor de su propio cerebro".
Nunca me he arrepentido. En la carrera encontré una motivación que no creo que hubiera encontrado en otro lugar. Ese sentimiento de emoción cuando te demuestran algo que durante mucho tiempo te has creído. No tener que memorizar nada, sólo pensar. Ser capaz de resolver problemas que nunca antes había visto. Entender el mundo que nos rodea. Por todo ello, los años de universidad no sólo me formaron como profesional, también como persona.
Durante la carrera tuve la oportunidad de profundizar en diversas ramas, como geofísica, astrofísica, física cuántica… Y dentro de ellas se pueden estudiar muchos temas más específicos. A veces ese amplio abanico de estudios es abrumador, hay tanto conocimiento por descubrir que puede resultar complejo elegir. A lo mejor te encuentras ahora en ese mismo punto. Mi consejo es que vayas a aquel sitio que te inspira, que te hace pensar y te relaja, pero ve solo, sin nadie. Y deja volar la imaginación, ¿dónde te ves en 10 años?, ¿cómo te gustaría vivir?, ¿quién te gustaría ser? Ahí podrás encontrar esa motivación que será tu motor. Éste irá cambiando a compás del tiempo, pero recuerda, el tiempo nunca se para así que no lo pierdas.
Poco a poco me fui dando cuenta de que encajaba en la física aplicada. Me gustaba estar en los laboratorios tomando medidas, hacer programas para tratar los datos y sacar conclusiones sobre los resultados; además del interés por entender la parte más teórica. Por otro lado, me motivaba la idea de poder aportar algo a la sociedad y de que el trabajo que hiciera pudiera tener una aplicación directa a un problema actual. Todo esto, junto con que las noticias sobre terremotos y erupciones volcánicas siempre me habían cautivado, me llevaron a decir un día: ¡yo quiero ser geofísica!
¿Qué es la geofísica y para qué sirve?
El prefijo geo- proviene del griego y significa ‘tierra’ o ‘La Tierra’ por lo que podemos deducir que es la parte de la física centrada en el estudio de la Tierra. Dentro de esta rama podemos encontrar otras muchas que a veces no son muy conocidas y después comentaré. Pero antes, ¿por qué es importante? Por un lado está el conocimiento en sí del lugar en el que vivimos, saber cómo era en el pasado, poder compararlo con el presente y poder imaginar cómo será en un futuro. Por otro lado, destaca el interés por proteger al ser humano de amenazas naturales como por ejemplo: terremotos, erupciones volcánicas, tormentas geomagnéticas, tsunamis…

Fig. 1. Representación gráfica de la magnetosfera terrestre. Las líneas rojas representan el campo magnético de la Tierra y las blancas el del Sol.
Y, en los últimos años, en la extracción y utilización de recursos naturales como petróleo, minerales, gas…
La Tierra es un planeta más del Sistema Solar, por lo que todo el conocimiento que se va adquiriendo sobre él lo podemos extrapolar a otros cuerpos celestes. Hay estudios sobre la tectónica de placas de los planetas rocosos, la actividad volcánica del satélite Io, la atmósfera de Venus…Son temas que típicamente se relacionan con astrofísica pero la base de todos ellos es la misma, la física. Por lo que geofísicos y geólogos también realizan una importante aportación. Es muy enriquecedor en una investigación, al igual que en cualquier tema cotidiano, contar con diferentes puntos de vista. En la actualidad esto se está fomentando y encontramos muchos trabajos que se conocen como multidisciplinarios.
Otro campo que actualmente está en auge dentro de la geofísica es lo que se conoce como ‘space weather’. Consiste en el estudio de las condiciones electromagnéticas del espacio interplanetario. Como puede verse en la Fig. 1, el campo magnético del Sol y la Tierra interaccionan formando diferentes estructuras alrededor de ésta que en su conjunto forman la magnetosfera.

Fig. 2. Fotomontaje de Saturno con una aurora (imágenes tomadas por el telescopio espacial Hubble).
Gracias a ella, la superficie del planeta está protegida de la actividad solar, aunque cuando ésta aumenta, la magnetosfera se debilita y las partículas expulsadas por el Sol llegan a la Tierra, entran por los polos y pueden causar importantes daños. Esto se conoce como tormenta geomagnética. La más fuerte de la que se tiene registro es conocida como el evento de Carrigton en 1859. Puesto que la radiación tarda unos minutos en llegar a la Tierra, podemos anticiparnos y evitar grandes daños en los sistemas eléctricos debido a las corrientes inducidas que se generan. Por ello, es importante tener satélites como el SOHO vigilando la actividad solar. Aunque no todo es destrucción, las auroras son una bella consecuencia de las tormentas magnéticas. De nuevo, esto también ocurre en otros planetas como puede verse en la Fig. 2.
Las ramas más clásicas de la geofísica son la sismología y la vulcanología. Hoy en día, tanto terremotos como erupciones siguen causando muchos daños a la población y quedan muchas preguntas sin respuesta. Gracias al avance de la tecnología y a la concienciación de muchos gobiernos sobre la importancia de esta ciencia, se dispone de redes de estaciones sísmicas distribuidas por muchos países que se encargan de recoger datos del movimiento del suelo, así como terremotos y ruido sísmico (Fig.3).

Fig. 3. Red de estaciones sísmicas de IberArray (proyecto Topo-Iberia financiado por el Ministerio de Educación y Ciencia).
Este último es generado principalmente por el oleaje de los océanos, creando ondas sísmicas que viajan a través de la tierra y podemos registrarlas en cualquier momento y en el cualquier punto de la superficie. Esto ofrece interesantes aplicaciones como la monitorización de volcanes en tiempo real. Si hay un ascenso de magma hacia la superficie, el medio circundante cambiará y, por tanto, el ruido registrado será diferente. Recientemente han surgido varios estudios que comentan la posibilidad de avecinar (que no prever) las erupciones volcánicas.
La Geofísica es una ciencia que debería promoverse y darse a conocer más. Se pueden conseguir grandes resultados de los cuales todos nos veríamos beneficiados. También debería de fomentarse la concienciación sobre diversos riesgos naturales. Siguen muriendo personas en España a causa de la falta de conocimiento sobre cómo actuar si hay un terremoto. Y, a la contra de lo que se piensa, hay terremotos todos los días del año. Además, esta ciencia ofrece un amplio espectro de posibilidades de estudio y trabajo entre los cuales es sencillo encontrar en cuál encajar.
Así, con este pequeño resumen de mi experiencia como geofísica pretendo promover un sentimiento de reflexión y autocrítica. Muchas veces no es sencillo ser conscientes de nuestras limitaciones pero no permitas que nadie las ponga por ti. Es importante pensar hacia dónde se quiere ir y a dónde se quiere llegar. Pasaréis muchas horas trabajando así que recuerda, el tiempo de trabajo es también tiempo de vida. Yo he encontrado mi motor en aprender, pensar, investigar y, todo ello, dentro del marco de la geofísica. ¿Cuál es el tuyo?
Pilar S. Sánchez-Pastor
Estudiante de Doctorado en Ciencias de la Tierra
ICTJA-CSIC
Ser historiador de la ciencia tiene un buen número de atractivos. Por un lado, hay que saber de ciencia – ¿cómo hacer la historia de "algo", si no se conoce ese "algo"? –, la actividad, en mi opinión (y es una opinión muy firme) que más ha hecho a lo largo de la historia por liberar a los humanos de ataduras materiales e intelectuales (de mitos). Es posible hacer lo que se denomina "historia internalista", o "historia de las ideas", esto es, reconstruir el pasado científico tomando en cuenta casi únicamente los contenidos de la ciencia (teorías, experimentos) y sus protagonistas, prestando muy poca atención al mundo – político, económico, filosófico, religioso… – en el que los científicos que crearon esa ciencia estaban inmersos. En mi primer libro, El origen y desarrollo de la relatividad (1983), yo mismo utilicé, básicamente, semejante enfoque. Pero si se pretende construir una historia lo más completa posible, es necesario incluir esos "otros elementos", no científicos si se quiere decir así, pero que pueden afectar en mil formas diferentes al proceso de creación científica. Ningún ejemplo mejor en este sentido que la historia de la física del siglo XX, una centuria en la que tuvieron lugar dos guerras mundiales, y otra llamada "Guerra Fría, que influyeron fuertemente en los contenidos y desarrollos de la física. Y para incluir esos "otros elementos" es necesario conocer cuanta más historia general, política y económica mejor, de manera que el historiador de la ciencia tiene que mostrar una gran polivalencia (lo que exige, por supuesto, esfuerzo). Diré en este punto que, recíprocamente, el historiador "general" y el económico debe, asimismo, conocer bien la historia de la ciencia y la tecnología. ¿Cómo, por ejemplo, se puede entender lo que sucedió en el siglo XIX, en los ámbitos de la política, la economía y la salud pública, sin tomar en consideración lo que significó para las comunicaciones la física del electromagnetismo, o los avances que se produjeron en la química orgánica (medicamentos, abonos artificiales, tintes) y en la denominada "medicina científica" (teoría microbiana de la enfermedad de Pasteur y Koch, vacunación, técnicas de asepsia)? La historia de la ciencia, en definitiva, permite comprender mejor el mundo, el internacional y también, si esa historia es más local, más nacional, la historia de los diferentes países, algo de lo que yo soy testigo, pues gracias a alguno de mis libros - Cincel, martillo y piedra. Historia de la ciencia en España (siglos XIX y XX) (1999), INTA. 50 años de ciencia y técnica aeroespacial (1997) y Energía nuclear en España. De la JEN al CIEMAT (2001) – pude comprender mejor la historia general de España.
Por cierto, yo reconocí que la historia de la ciencia debe ser así y, por así decir, he "compensado" el demasiado internalista enfoque de El origen y desarrollo de la relatividad sobre todo con otro libro: El poder de la ciencia. Historia social, política y económica de la ciencia (siglos XIX y XX) (2007).
He incluido la historia de la tecnología en los requisitos para comprender el pasado – y el presente – histórico. Es cierto que la historia de la tecnología constituye una disciplina diferente de la historia de la ciencia, pero ambas están relacionadas entre sí. La ciencia no puede vivir – no habría existido – al margen de las observaciones y los experimentos (la naturaleza es mucho más "imaginativa" de lo que cualquier científico teórico puede imaginar solo con su cerebro). Y para observar y hacer experimentos se necesitan instrumentos, esto es, tecnología. En el pasado abundaron los historiadores de la ciencia que centraban sus reconstrucciones sobre todo en los desarrollos teóricos, pero afortunadamente ese vicio ya no es tan frecuente. Lavoisier, quien puso en marcha la química moderna (la notación que introdujo es la misma que se utiliza ahora, más de dos siglos después) tuvo que realizar muchos experimentos, con instrumentos como calorímetros, gasómetros o una balanza química de precisión. En su casa-laboratorio de Downe, Charles Darwin llevó a cabo innumerables experimentos con plantas, semillas o criando palomas. Y Santiago Ramón y Cajal, ¿habría podido llegar a la teoría neuronal, que aún nos guía en la comprensión del cerebro, sin disponer de un buen microscopio? Sin duda, no. De hecho, una de sus luchas fue intentar conseguir uno de los mejores microscopios de la época. Así, el 1 de enero de 1885, escribía a uno de sus primeros discípulos, el jesuita Antonio Vicent Dolz, que se encontraba en Lovaina para completar su formación: "¡Ah! ¡Quién tuviera esos magníficos objetivos a los que Flemming, Strassburger y Carnoy deben sus descubrimientos! Aquí desgraciadamente las facultades no tienen material." Afortunadamente, en 1877 consiguió un microscopio Zeiss, que le regaló la Diputación de Zaragoza en agradecimiento al informe que había preparado sobre la epidemia de cólera y la vacunación de Jaume Ferrán. "Al recibir aquel impensado obsequio", escribió en sus Recuerdos, "no cabía en mi de satisfacción y alegría. La culta Corporación aragonesa cooperó eficacísimamente a mi futura labor científica, permitiéndome abordar, con la debida eficiencia, los delicados problemas de la estructura de las células".

Fig.1. Máquina de vapor de Watt, procedente de la Fábrica Nacional de Moneda y Timbre, expuesta en el vestíbulo de la Escuela Técnica Superior de Ingenieros Industriales de Madrid. Crédito: De Nicolás Pérez, CC BY-SA 3.0, https://commons.wikimedia.org/w/index.php?curid=195711
Sin la ciencia, la tecnología se habría limitado a máquinas demasiado básicas (palancas, norias hidráulicas, molinos de viento…) como para producir una civilización de las características de la actual. Consecuentemente, se tiende a pensar que la ciencia es siempre previa a la tecnología, que primero se dispone de la ciencia pura, básica, y que cuando ésta se aplica se convierte en tecnología, pero no siempre es así. El origen de la denominada Revolución Industrial (siglos XVIII y XIX), que cambió el mundo, reside en la máquina de vapor, que se basaba en la utilización de la fuerza elástica del vapor de agua como fuerza motriz. La idea que la sustentaba era la de intercambios de energía, pero la termodinámica, la rama de la física que se ocupa de tales intercambios, no existía todavía, nació, por el contrario, con el fin de hacer más eficientes aquellas máquinas.
De lo que he dicho debería quedar claro que entre las virtudes de la historia de la ciencia se halla el que permite entender mejor la propia ciencia, sus contenidos, orígenes y contextos. Al científico, yo le recomendaría que se ocupase un poco de estudiar la historia de la ciencia a la que se dedica: la entenderá mejor. Esto es lo que me sucedió a mí, y, me lo han dicho, a muchos otros, con otro de mis libros: Historia de la física cuántica, I: El período fundacional (1860-1926) (2001). A cualquiera que haya tenido que estudiar la mecánica cuántica, le parecerá un milagro, incomprensible, cómo pudo llegar a ser esta teoría; ¿a quién se le habría ocurrido? Mi libro me permitió comprenderlo. Y eso me hizo mejor físico.
José Manuel Sánchez Ron
Doctor en Ciencias Físicas
Catedrático de Historia de la Ciencia, Universidad Autónoma de Madrid
Miembro de número de la Real Academia Española sillón G)
Premio Nacional de Ensayo 2015
Yo quiero ser Ingeniera de Materiales, y es lo que soy, bueno, en realidad es en lo que trabajo, en enseñar ciencia y tecnología de materiales, pues mis estudios son en Ingeniería de Telecomunicaciones y mi doctorado en control automático. Con esta breve presentación quiero animar a las chicas a que se decanten por las ingenierías, que afortunadamente es lo que ya ocurre, pero que apenas estábamos representadas cuando yo estudiaba, y también animo a las ingenieras e ingenieros a que busquen la disciplina de la ingeniería que de verdad les apasiona, aunque su formación inicial fuese otra (los ingenieros valemos para todo, como se suele decir, lo mismo planchamos un huevo que freímos una corbata).
En mi caso concreto, por si os sirve de inspiración a alguna o alguno, como experta en control y en automática lideraba un proyecto de investigación multidiscipliar con especialistas en varios tipos de ingeniería, orientado a determinar errores en la soldadura mediante técnicas de emisión acústica (es decir, con sensores que "escuchaban" el ruido de la soldadura). El proyecto era apasionante: un sistema automático realizaba soldadura, y se iba captando todos los sonidos producidos; cuando se detectaban errores en la soldadura se relacionaban con el sonido que se escuchaba en ese momento, y se empleaba esa información para entrenar un sistema de inteligencia artificial (en nuestro caso basado en redes neuronales) que iba aprendiendo a detectar los sonidos que correspondían a los errores. Así una vez entrenado el sistema, ya se podía emplear en sistemas reales de soldadura, y cuando el sonido era interpretado por nuestro sistema como correspondiente a un error, se verificaba que realmente existía ese error (lo que ocurría prácticamente siempre, pues nuestro sistema experto funcionaba muy bien) y se desechaba la pieza soldada. Y aunque en ese equipo yo era la responsable de las señales acústicas, me "enamoré" de la soldadura a lo largo de ese proyecto, y cuando pude me dediqué a la ciencia y tecnología de materiales, que es lo que enseño en la actualidad en la Universidad de La Rioja.
La Wikipedia nos cuenta de manera muy concisa qué es la ingeniería de materiales y cuáles son sus objetivos: "La ingeniería de materiales es una rama de la ingeniería que se fundamenta en las relaciones propiedades-estructura y diseña o proyecta la estructura de un material para conseguir un conjunto predeterminado de propiedades. Esta ingeniería está muy relacionada con la mecánica y la fabricación. Los objetivos del ingeniero de materiales son dominar al máximo nivel las técnicas avanzadas de producción y transformación de los materiales y ser capaz de contribuir al desarrollo de materiales nuevos y de nuevos procesos de producción. En el mundo cambiante de las nuevas tecnologías del siglo XXI, el Ingeniero de Materiales va a ser un agente imprescindible en la selección de materiales para todas las áreas de la ingeniería y en particular en el mundo del diseño".
Un buen profesor de electrónica que tuve nos comentaba que por mucho que se avance en electrónica, o en computación, la ciencia y tecnología de materiales siempre será fundamental, porque TODO, ya sea un transistor, un microchip, o una memoria de estado sólido, se produce con materiales, y los nuevos materiales están presentes en prácticamente todos los avances de la ingeniería.
Los sectores industriales más importantes en los que podréis trabajar si os dedicáis a la Ingeniería de Materiales son, entre otros, los siguientes:
-Construcción
-Obra civil
-Industria automovilística
-Transporte ferroviario, aeronáutico y aeroespacial.
-Ingeniería de productos.
-Control y garantía de calidad y fiabilidad de materias primas, procesos industriales y productos.
-Producción de la energía.
-Electrónica y Telecomunicaciones.
-Salud
Los materiales se clasifican en un primer lugar en metales, materiales cerámicos y polímeros, pues cualquier material puede clasificarse en uno de esos grupos, si bien las clasificaciones pueden ser mucho más complejas. Por ejemplo es habitual considerar junto a esos 3 grupos los semiconductores (pese a que pertenecen a los materiales cerámicos) y los materiales compuestos (pese a que son simplemente mezclas de materiales pertenecientes a las otras categorías). Las características principales de esos grupos son:
-Metales: Son buenos conductores del calor y la electricidad, poseen alta densidad, son sólidos a temperatura ambiente (excepto el mercurio), y sus sales forman iones electropositivos en disolución.
-Materiales cerámicos: En su sentido estricto se refiere a la arcilla en todas sus formas, aunque el uso moderno de este término incluye a todos los materiales inorgánicos no metálicos que se forman por acción del calor (por sinterización).
-Polímeros: son macromoléculas, generalmente orgánicas (como el almidón, la celulosa, la seda y el ADN) aunque también sintéticas (como el nailon, el polietileno y la baquelita) formadas por la unión mediante enlaces covalentes de una o más unidades simples llamadas monómeros, que forman largas cadenas que se unen entre sí, consiguiendo elevadas masas moleculares, que pueden alcanzar (incluso millones de unidades de masa atómica).
-Compuestos: se forman por la unión de dos o más materiales para conseguir la combinación de propiedades que no es posible obtener en los materiales originales.
-Semiconductores: se comportan como un conductor o como un aislante dependiendo de diversos factores, tales como el campo eléctrico o magnético, la presión, la radiación, o la temperatura.
Tras esa breve descripción sobre cada uno de esos tipos de materiales (por desgracia no puedo extenderme más) creo que es muy importante para los actuales estudiantes o quienes se plantean serlo, y por tanto futuros profesionales, las competencias de esta profesión, entre las que destacaría las siguientes (entre muchísimas otras, por supuesto):
-Análisis y selección de materiales para aplicaciones específicas
-Diseño, desarrollo de materiales específicos
-Caracterización, evaluación y certificación de materiales según sus aplicaciones
-Diseño y desarrollo de procesos de producción y trasformación de materiales
-Inspección y control de calidad de materiales
-Procesos de producción y transformación de materiales
-Determinación de productos y procesos idóneos para cada material
-Definición, desarrollo, y elaboración de normativas y especificaciones de los materiales y sus aplicaciones
-Diseño, cálculo y modelizado de elementos, componentes mecánicos, estructuras y equipos
-Evaluación de la seguridad, durabilidad y vida útil de materiales
-Diseño, desarrollo y control de procesos de recuperación, reutilización y reciclado de materiales
-Dirección o gestión de industrias relacionadas con los puntos anteriores
-Dictámenes, peritaciones e informes en relación con los puntos anteriores
-Y por supuesto, docencia e investigación en ciencia y tecnología de materiales (que es mi profesión :-)
Por ejemplo, en mi grupo de investigación hemos trabajado con caracterización de procesos de soldadura de elementos diferentes (como cobre y aluminio) por fricción-agitación (es decir, metiendo una herramienta giratoria que gira tan rápido que "derrite" y mezcla los materiales a medida que va avanzando por ellos), o también caracterización de diferentes materiales al incluir ciertas cantidades de ese novedoso y prometedor material, grafeno.
Y empleando esos estudios hemos sido capaces de desarrollar y patentar pinturas que cambian totalmente sus propiedades eléctricas (conductividad eléctrica) en contacto con humedad, lo que las hace ideales para aplicaciones como pintura de carretera o de tejados en zonas con peligros por hielo.
Por último quería hacer notar la importancia que en la Ingeniería de Materiales actual tiene la simulación por computación. Hoy en día muchísimos de los ensayos que se realizaban en laboratorio se realizan en el computador. Por ejemplo para determinar el comportamiento de ciertas piezas en función del tipo de material (pongamos una pieza de avión que queramos ver su comportamiento con acero, aluminio o titanio) se emplea un modelo que se simula mediante el método de elementos finitos y nos permite no sólo conocer el comportamiento, sino poder variar parámetros estructurales, de tamaño o de material para buscar la solución óptima.
A modo de ejemplo de los avances que la Ingeniería de Materiales ha permitido, presento una fotografía, Fig.1, (perteneciente a Wikipedia) del primer puente de hierro, el famoso Iron Bridge de Coalbrookdale, de 1777, de 60 m de longitud hecho en hierro fundido, y dos fotografías, Fig. 2 y 3, (también de Wikipedia) del viaducto sobre el río Almonte.
Mercedes Pérez de la Parte
Doctora Ingeniera de Telecomunicaciones; Universidad de la Rioja
Yo quiero ser Ingeniera de Telecomunicación, eso le dije a mi madre cuando tenía 14 años y me preguntó acerca de qué quería estudiar. Desde ese momento el objetivo estaba claro y la línea a seguir debía ser recta. Tenía que conseguir la meta marcada en un plazo de 4 años, al cumplir los 18 debía estar matriculada en una de las carreras más demandadas en aquel momento.
No podía imaginar por aquel entonces cuánto trabajo y cuánto sacrificio iba a tener que afrontar. Para mí era un gran reto, dado que debía superar numerosos obstáculos. Pese a que siempre he tenido mucha facilidad para superar con éxito las asignaturas relacionadas con las matemáticas o la física, me costaba horrores empaparme de otras como historia o filosofía. Sin embargo, tenía que obtener notas brillantes en todas ellas, porque mi objetivo requería un expediente con una nota muy elevada. Así pues, ideé un plan para afrontar aquellas asignaturas que me resultaban más tediosas. El plan consistía en imaginar que era una especialista en historia, en filosofía, o en literatura, que tenía que enfrentarse a una prueba que cambiaría el rumbo de la historia. Cualquier aventura que imaginase me servía para motivarme a estudiar y sacar el máximo provecho de las horas dedicadas a ello. Esto me enseñó a motivarme y a concentrarme, dos cualidades que no he abandonado y que me permiten superarme día a día.
Pero volvamos al principio, ¿por qué quería estudiar telecomunicaciones? En aquella época empezaban a comercializarse los primeros ordenadores, y se hicieron populares algunos lenguajes de programación que os sonarán a chino. A mi padre le encanta la tecnología, por lo que tuve la suerte de que se comprara un ordenador con el cual comencé a realizar mis primeros pinitos en programación. ¡Aquello me entusiasmó!, ser capaz de, con cuatro líneas de código, realizar un pequeño juego para entretener a mi hermana... para mí era algo realmente maravilloso. A partir de ahí seguí realizando pequeños avances, pero tuve que auto-limitarme para no ocupar demasiado tiempo programando, nada debía desviarme de mi meta.
Poco tiempo después tuve un profesor de tecnología que me introdujo en el mundo de la electrónica. El poner cuatro componentes en una placa y poder hacer que se encendiera un led, que sonase una melodía o que se activase un motor era un mundo nuevo e inesperado. Poco a poco empecé a entrever el enorme futuro que podrían tener mis dos pasiones unidas, si llegara a dominar la programación y la electrónica podría ser capaz de desarrollar gran cantidad de inventos. Y lo mejor de todo es lo bien que lo iba a pasar mientras trabajase en estos futuros proyectos. Así fue como comenzó mi vocación en ingeniería, y más concretamente en Telecomunicaciones. Por aquel entonces no podía ni imaginar el gran desarrollo que se iba a producir en este campo. Los teléfonos móviles, las televisiones inteligentes, la robótica y el internet eran cosas de ciencia ficción.
Con mucho esfuerzo y tesón fui capaz de conseguir la primera parte de la meta marcada, pero el primer día en la Universidad me di cuenta de que el camino no había hecho nada más que empezar. En primer lugar éramos 200 estudiantes con unos expedientes brillantes (la mayoría mucho más brillantes que el mío) en una titulación tremendamente exigente, en la que se impartían una serie de asignaturas con un contenido teórico brutal, sobre el que había que poner mucha imaginación para encontrarle la aplicación práctica. Ese aspecto me desesperaba. Tener que pasar horas haciendo integrales triples sin encontrarle la aplicación práctica era frustrante. Lo anterior unido al desproporcionado nivel que los profesores exigían en los exámenes, hizo que muchos de mis compañeros fueran abandonando el primer curso de carrera, desviándose hacia títulos que podrían considerarse más "fáciles" o más aplicados.
Pero yo seguí insistiendo, en el fondo algo me decía que, al final del camino se hallaba la meta, aquella que me proporcionaría la capacidad para poder realizar todos los inventos soñados. Así pues, poco a poco, conseguí ir aprobando los primeros cursos, y llegar a los cursos más altos, en los cuales nos dividíamos en especialidades. Yo elegí la especialidad de electrónica, en la cual las clases eran menos numerosas y eso permitía que los profesores del departamento de ingeniería electrónica nos propusieran otros modos de trabajar. Pequeños proyectos que para mí eran verdaderos tesoros, ya que me permitían poder al fin desarrollar mis pequeños inventos.
De todos los años de universidad, lo mejor de todo fueron los grupos de trabajo que montábamos los alumnos para realizar los proyectos. El trabajar en equipo, aprender a organizar nuestro tiempo y ayudarnos los unos a los otros a conseguir el objetivo fue una experiencia que más tarde he podido repetir en mi trabajo profesional y que nunca deja de sorprenderme. Cuando tienes un buen equipo de trabajo eres capaz de alzar el vuelo y llegar mucho más lejos de lo que habías soñado, y encima disfrutas de lo lindo.
Al terminar la universidad tuve la suerte de poder entrar en un grupo de investigación gracias al cual aprendí la importancia de la investigación básica y de la colaboración con otras instituciones. En mi caso estuve un año trabajando en colaboración con los cirujanos de un hospital para realizar algoritmos de detección de arritmias cardíacas, vamos lo que todos conocemos por infartos de corazón. Esto me permitió unir mis conocimientos a las ciencias de la salud, porque sí, lo bueno que tiene ser ingeniera de telecomunicación es que no hay campo del conocimiento que no necesite de nuestra colaboración. En esta época descubrí que, todo el esfuerzo puesto en aprender aquellas asignaturas teóricas que tan pesadas me parecían, había moldeado mi cerebro, de manera que era capaz de enfrentarme sola a cualquier problema. Sabía buscar información, procesarla, entenderla y aplicarla para encontrar la solución al problema en un espacio de tiempo realmente breve. Además los contactos hechos en la universidad me proveían de una red de profesionales a los que acudir en caso de duda. Mi vida estaba encauzada y mi objetivo cumplido, o eso creía yo.
Sin embargo la vida da muchas vueltas y nunca sabes en qué momento puedes encontrar una oportunidad que le puede dar la vuelta a todo lo que conoces. De la noche a la mañana me enteré de que se había publicado una oferta de trabajo en la universidad, para ocupar una plaza de profesor en el departamento de ingeniería electrónica, sí, aquel departamento del que tan buen recuerdo tenía porque me había permitido realizar mis primeros proyectos durante la carrera. Tenía que conseguirlo, tenía que optar a la plaza y ganarla.
Y lo hice, conseguí un contrato con el departamento y comenzó otra carrera, esta si cabe aún más larga que la anterior. Ahora había que cursar estudios de Doctorado y hacer la Tesis, todo ello a la vez que impartía clases de electrónica.
De nuevo muchas horas de estudio, de cursar asignaturas teóricas, de publicar los resultados de mi investigación sin tener muy claro si iban a ser alguna vez útiles. En paralelo desarrollaba proyectos en las asignaturas que impartía, intentando que mis alumnos no se sintieran tan desconectados y perdidos como yo el primer año. Y poco a poco, año a año, conseguí el doctorado, la tesis, la plaza de titular, un niño, otro niño, sí porque que sea ingeniera de telecomunicación no significa que no pueda ser MADRE.
Y claro, parón en mi carrera, no os voy a engañar, la llegada de un nuevo miembro a la familia trastoca todos tus planes, tus metas y tus expectativas. Pero vale la pena más que nada en el mundo. En cuanto te das cuenta te encuentras preguntándoles: ¿y tú qué quieres estudiar?, y ellos te dicen "Yo quiero ser…" y el ciclo comienza de nuevo.
Todos estos recuerdos me llevan a querer exponeros lo que ha cambiado la universidad en los veinte años que llevo dando clase. Actualmente, aunque siguen impartiéndose asignaturas puramente teóricas, que como ya hemos visto sí que sirven para algo, la mayoría de las titulaciones incluyen numerosas prácticas, proyectos y otras metodologías que os permitirán ver la aplicación de vuestros estudios mucho antes de lo que pude hacerlo yo. Además, muchos de los profesores con los que os encontraréis son conscientes de la importancia de aplicar su conocimiento a la sociedad, por lo que cada vez son más las colaboraciones que se producen y que os abren un sinfín de campos de aplicación.
Por otro lado, si no tenéis claro qué queréis estudiar pero os gusta la tecnología, las matemáticas y la física, estoy convencida de que la ingeniería de telecomunicación no os defraudará. Los conocimientos que podéis adquirir en esta carrera se pueden llegar a aplicar a todos los campos de la ciencia, os reto a que lo intentéis, seguro que sois capaces.
Mª Asunción Pérez Pascual
Doctora Ingeniera de Telecomunicación
Profesora Titular de Universidad, Universidad Politécnica de Valencia
Yo quiero ser Ingeniera Óptica y jugar con la luz, porque básicamente es a lo que nos dedicamos: a utilizar las propiedades de la Luz en multitud de desarrollos científicos y tecnológicos. La Ingeniería Óptica se ocupa de las aplicaciones de la Óptica y la Fotónica: la Óptica es la ciencia que se ocupa del estudio de la Luz y de los fenómenos luminosos, y la Fotónica es la ciencia de la generación, control y detección de partículas luminosas, "fotones". La Ingeniería Óptica, por tanto, trata de la Luz.
La Luz está presente en todo lo que nos rodea, desde que nos levantamos hasta que nos acostamos y, ya desde la Antigüedad, el ser humano ha sentido curiosidad científica por la Luz y sus aplicaciones. Una de las primeras preguntas filosóficas que se planteó el ser humano tiene que ver con la visión, con la percepción del mundo exterior y en por qué vemos, o qué es la Luz: el ser humano percibe el 80% de la información del mundo que le rodea gracias al sentido de la vista, y, sin duda, esta es una de las razones que impulsó a los primeros científicos a intentar comprender por qué ve el ser humano y qué lo hace posible.
¿Cómo era un Ingeniero Óptico en la Antigüedad?
Existen algunas evidencias que sugieren que los primeros ingenieros ópticos existían ya hace 4000 años y que muchas de las grandes construcciones de la Antigüedad (Pirámides egipcias y mayas, Stonehenge, etc.) fueron construidas teniendo en cuenta los principios básicos de la Ingeniería Óptica. Estos pioneros sabían ya que la luz viaja en línea recta, entendían el ciclo de las estaciones y su dependencia con el ciclo solar, y conocían algunas de las interacciones entre la Luz y su entorno y tomaban ventaja de las mismas, creando las primeras aplicaciones ópticas. La fabricación de lentes, de diferentes tipos y aplicaciones, constituyó el primer paso en el desarrollo de instrumentos ópticos, gracias a los cuales se sentaron las bases de los primeros tratados de Óptica sobre la Luz y la Visión.
En la Grecia clásica se produjeron avances notables en el estudio de la Luz: Euclides, en su libro Óptica (˜siglo III a.c), ya aludía al concepto de "rayo de luz" y al hecho de que la Luz viaja en línea recta. Las bases de la Óptica Geométrica ya eran un hecho. Más adelante, en la Edad Media comenzó el desarrollo de la Óptica Física y la Óptica Fisiológica, manteniendo aún unidos el estudio de la Visión y del agente físico que la provoca, la Luz. Es en la Edad Media cuando Alhacen (siglo X) enuncia la idea de que las fuentes de luz iluminan los objetos y que la luz reflejada por estos llega a los ojos, permitiendo la visión en contraposición a la escuela platónica que consideraba la visión como una propiedad del alma, que hacía que los rayos emergían de los ojos del observador hasta alcanzar los objetos.
La Óptica Geométrica se basa en el concepto de rayo de Luz y se utiliza principalmente para explicar los fenómenos de propagación de la luz, las trayectorias que sigue esta al propagarse y la reflexión y la refracción lumínicas sobre distintos medios materiales. Sus aplicaciones tecnológicas han sido innumerables, sobre todo en la fabricación de instrumentos ópticos para la formación de imágenes (por ejemplo cámaras fotográficas, microscopios, telescopios). Sin embargo la Óptica Geométrica no era capaz de explicar toda la casuística óptica.
En el momento en el que aparece la Óptica Difractiva, se pasa de la Óptica Clásica a la Óptica Moderna, ya en el siglo XX. La Óptica Ondulatoria se introdujo para explicar fenómenos de difracción, interferencia y polarización de la luz y, en combinación con la idea de que la Luz está compuesta por ondas electromagnéticas, permite explicar fenómenos en los que la Luz interactúa con la materia (dispersión de la Luz en la atmósfera o absorción de la Luz en materiales). Esto supuso un importantísimo avance de las tecnologías ópticas relacionadas con el procesado óptico de imágenes o la metrología óptica (por ejemplo gracias a la interferometría). Para ir un paso más allá y explicar fenómenos de interacción de la Luz con la materia, a nivel microscópico, se desarrolló la Óptica Cuántica, que permitió explicar la naturaleza dual onda-partícula de la Luz: las partículas luminosas pueden exhibir comportamientos típicos de ondas en unos casos y de partículas compactas y localizadas en otros. La Óptica Cuántica ha permitido la evolución de la Fotónica y las tecnologías derivadas de la misma como los láseres, las tecnologías de las comunicaciones ópticas o los detectores de radiación basados en semiconductores.
¿Qué hace un Ingeniero Óptico hoy en día?
En la actualidad, los Ingenieros Ópticos trabajan en multitud de áreas relacionadas principalmente con el diseño de sistemas ópticos, la óptica visual, la óptica de materiales y láminas delgadas, la fabricación y los controles de calidad ópticos, así como la óptica astronómica, aeronáutica y espacial.
El diseño de sistemas ópticos comprende el diseño de componentes de instrumentos ópticos como lentes, espejos, cámaras fotográficas, microscopios, telescopios y otros instrumentos más complejos basados en las tecnologías de la Luz, como sensores ópticos y sistemas de medición, láser, sistemas de comunicación de fibras ópticas, o sistemas de almacenamiento de datos. La complejidad de los sistemas ópticos depende en gran medida de la finalidad de los mismos y de la tarea a llevar a cabo.
La Ingeniería Óptica es imprescindible en el diseño de sistemas complejos que permitan estudiar la Óptica/Física de la visión, muy similar a la de un sistema de fotografía, y la interpretación que hace el cerebro de la información que recibimos del exterior, el procesado neuronal. La Óptica y la Visión permanecen igual de unidas que en la Antigüedad, inherentes una a la otra, con la ventaja de que las tecnologías ópticas existentes permiten un estudio más detallado de las mismas. De hecho, algunas tecnologías ópticas utilizadas en Astronomía (Óptica Adaptativa) o Metrología (Interferometría), se utilizan de manera convencional para estudiar el sistema visual humano.
Uno de los temas candentes en Ingeniería Óptica tiene que ver con la selección, diseño y desarrollo de material con nuevas propiedades ópticas y físicas, la Óptica de materiales y láminas delgadas. Cuanto más complejos son los sistemas ópticos, mayores las exigencias en cuanto a las características de los materiales empleados: transparencia, dureza, índice de refracción, biocompatibilidad, propiedades cromáticas, entre otros.
En esa línea, la Ingeniería Óptica de materiales está muy relacionada con la fabricación de nuevos materiales, pero también en técnicas ópticas de control de calidad, como por ejemplo las que utilizan patrones de interferencia de Moiré para detectar fallos estructurales en sistemas complejos (por ejemplo controles de calidad en la fabricación de fuselajes de aviones).
Por supuesto, un campo clásico de aplicación de la Ingeniería Óptica es la Óptica Astronómica, Aeronáutica y Espacial. ¿Quién no ha oído hablar de las misiones de la NASA a diferentes planetas? ¿Y los grandes telescopios astronómicos como el Hubble? ¿Habéis ido a un planetario? En todas esas áreas de trabajo, exploración e investigación es imprescindible la Ingeniería Óptica.
En resumen, la Luz y la Óptica están en todas partes y, por tanto los trabajos relacionados con ellas también.
¿Cómo llegar a ser un Ingeniero Óptico?
El diseño y construcción de dispositivos para aprovechar las propiedades de la luz es una tarea compleja que requiere conocimientos extensos de Óptica y Física. Sin embargo, debido a la complejidad de los sistemas ópticos otros conocimientos son también necesarios.

Fuente laser de supercontinuo del Sistema Óptica Adaptativa policromático del Grupo de Óptica Visual y Biofotónica del Instituto de Óptica “Daza de Valdés” del Consejo Superior de Investigaciones Científicas (CSIC). Tesis doctoral “Polychromatic Adaptive Optics to evaluate the impact of manipulated optics on vision”, M. Viñas.
Las fuentes de luz utilizadas en este tipo de sistemas pueden ser de múltiples tipos y capacidades (principalmente fuentes láser) por lo que son necesarios conocimientos de Fotometría y Radiometría, así como de Seguridad y protección láser.
El diseño de sistemas tan complejos requiere a menudo el conocimiento de software de diseño óptico (Zemax, Oslo) que permite conocer las capacidades teóricas del sistema antes de su desarrollo.
Muchos sistemas ópticos incluyen fuentes de luz (láseres, fuentes de fibra), sistemas optomecánicos, microprocesadores, fibras ópticas, detectores, cámaras científicas, sistemas de proyección de imagen, y/o sistemas de medida (intensidades, potencias) entre otros. Son imprescindibles conocimientos de programación (Matlab, C#) que permitan el control de semejantes dispositivos.
Pero lo más apasionante de ser Ingeniero Óptico es que, puesto que la Óptica tiene infinidad de aplicaciones, durante tu carrera profesional tienes la oportunidad de aprender y desarrollar multitud de proyectos de temáticas muy alejadas entre sí: desde desarrollar un telescopio para observar las estrellas hasta diseñar un sistema para mejorar la óptica del ojo humano.
Bibliografía:
[1] Unidad Didáctica Ciencia con luz propia. Aplicaciones tecnológicas de la luz: Fundación Española para la Ciencia y la Tecnología (FECyT) M-26468-2015
[2] Optical engineering. R. M. Scott. Applied optics, 1962 (1) 4
[3] Optical engineering and the Optical Society of America. Jay M.J.M. Eastman. Appliedoptics, 1982 (21) 22
María Viñas Peña
Doctor en Ciencias Físicas, Máster Ingeniería Óptica, Grado en Óptica
Investigador Postdoctoral, Laboratorio de Óptica Visual y Biofotónica,
Instituto de Óptica, Consejo Superior de Investigaciones Científicas
(IO-CSIC)
Muchas veces a lo largo de mi carrera, cuando alguien me ha preguntado a qué me dedico o en qué tipo de empresa o institución trabajo y he contestado "en la Agencia Europea del Espacio" o "en un operador de telecomunicaciones vía satélite", casi inmediatamente después me he encontrado explicando cómo es posible que los satélites no se caigan al suelo o para qué sirven los satélites o cuantos satélites hay orbitando la Tierra. Y claro, aquí uno puede pasarse horas, incluso días, argumentando y aportando datos sobre usos y aplicaciones de esos ingenios. Justamente son esos usos y aplicaciones los que marcan una característica fundamental de los satélites: su órbita.
Las órbitas de los satélites, los planetas y las estrellas se rigen por las leyes de la mecánica espacial. Las leyes de Kepler [1], enunciadas a principios del siglo XVII, describieron por primera vez de forma matemática el movimiento de los planetas de nuestro Sistema Solar alrededor del Sol. Unas décadas después, en 1687 Isaac Newton publicó su "Philosophiae Naturalis Principia Mathematica" [2]; quizás el libro de ciencia más importante de la historia, en el que se formula la ley de la gravitación universal. En ella se establece la relación entre la fuerza de atracción entre dos objetos masivos, sus masas (directamente proporcional) y la distancia que les separa (inversamente proporcional al cuadrado de ésta).
Cuando lanzamos una piedra desde lo alto de un acantilado vemos que, por mucha fuerza que apliquemos a nuestro tiro, la piedra acaba cayendo al fondo de barranco. Aun siendo un gran campeón de atletismo difícilmente podríamos impulsar la piedra a más de 35 metros por segundo. Ahora bien, si no hubiera aire en la atmosfera que ralentizase la piedra y fuésemos, algo parecido al primo de Superman, capaces de impulsar la piedra a 8 kilómetros por segundo, al cabo de poco más de 80 minutos deberíamos agachar la cabeza para evitar que la piedra nos diese en la nuca. ¡Esa piedra hipersónica se habría convertido en un satélite artificial de la Tierra! En una órbita circular, la magnitud de velocidad es inversamente proporcional a la raíz cuadrada del radio de la órbita, mientras que el cuadrado del periodo orbital es proporcional al cubo del radio de la órbita. Además del periodo y el radio, otras dos características fundamentales (hay más) de una órbita son su inclinación respecto al plano ecuatorial y su forma o excentricidad (circulares, elípticas, etc.).
En el sector aeroespacial, como en otros muchos, el desarrollo tecnológico y la imparable imaginación e inventiva del hombre ha permitido dar solución a antiguas y nuevas necesidades y crear nuevas aplicaciones. De esta manera, es imposible hablar de un único tipo de satélites. La especialización de los mismos ha ido de la mano del uso de diferentes recursos orbitales.
Típicamente los satélites para mapeado y observación de la tierra, satélites de reconocimiento (también llamados satélites espía) y algunos satélites meteorológicos giran alrededor de nuestro planeta en las llamadas órbitas bajas o LEO ("LowEarthOrbit"), cuya altura sobre la superficie terrestre está entre unos 200 km y 2.000 km. Las órbitas de estos satélites tienen una gran inclinación (típicamente cerca de 90 grados) para poder barrer en su periplo toda la superficie terrestre. En ese rango de alturas encontramos también a la Estación Espacial Internacional ("InternationalSpaceStation" o "ISS") a unos 400 km de altura y una inclinación de 51.6 grados para facilitar la trayectoria de los lanzamientos desde el cosmódromo de Baikonur en Kazakstán. Con el objeto de proporcionar servicios de telecomunicaciones en cualquier punto de la superficie terrestre, los 72 satélites de la constelación Iridium ocupan seis planos orbitales inclinados 86.4 grados a una altura de 781 km.
Los principales sistemas satelitales de geo localización y navegación están formados por constelaciones de satélites en órbitas de altura media o MEO ("MediumEarthOrbit"). Los 32 satélites del sistema estadounidense GPS ("GlobalPositioningSystem") ocupan seis planos orbitales con 55 grados de inclinación a una altura de 20.200 km. Los satélites del sistema ruso GLONASS están un poco más abajo, a 19.100 km con una inclinación de 64.8 grados, mientras que los del europeo Galileo están un poco más arriba, a 23.222 km con una inclinación de 56 grados.
Quizás los satélites más populares, si es que podemos llamarlos así, son los geoestacionarios. La órbita geoestacionaria o GEO ("Geo-stationaryOrbit") fue propuesta por primera vez por el ingeniero esloveno Herman Potočnik en 1928 y más tarde popularizada por el famoso científico y escritor Arthur C. Clarke. El origen de la idea es poder tener un punto muy alto en el espacio que, aparentando estar en reposo desde la superficie terrestre, pueda ver puntos muy distantes entre sí. Esto permitiría la transmisión de señales entre sitios sin línea de vista a través de ese punto estático como si fuera una torre de comunicaciones colgada en el espacio. Resulta que resolviendo las ecuaciones de Newton, una órbita circular con una altura de 35.786 km sobre nivel del mar tiene un periodo de 24 horas, es decir, es geo síncrona. Si además, la órbita está en el plano ecuatorial (inclinación cero) los cuerpos que desde allí circunvalan la Tierra aparecen estáticos respecto a un observador en la superficie terrestre. El anillo geo estacionario ha sido y es utilizado por centenares de satélites de telecomunicaciones que ofrecen servicios en todo el mundo de difusión de cadenas de televisión y radio, de comunicaciones móviles con barcos y aeronaves y todo tipo de servicios de telecomunicaciones en zonas remotas del planeta.
Para solventar el problema del bajo ángulo de elevación en la recepción de los satélites geo estacionarios en territorios alejados del ecuador, en Rusia usan satélites en órbitas elípticas o HEO ("HighlyEllipticalOrbit") llamadas Molniya que poseen perigeos (los puntos más cercanos a la superficie terrestre) de unos 1.000 km y apogeos (los puntos más alejados) de hasta 24.000 km y una inclinación de 63.4 grados. En Estados Unidos, la empresa Sirius XM Satellite Radio emplea satélites en órbitas elípticas geo síncronas o HEGO ("HighlyEllipticalGeosynchronousOrbit") llamadas Tundra para proporcionar servicios de radiodifusión a más de 30 millones de usuarios móviles.
El abanico de órbitas no se acaba aquí. En estas líneas me he referido únicamente a las órbitas alrededor de la Tierra. Las próximas generaciones de ingenieros aeroespaciales sin duda se preocuparán más por las órbitas abiertas interplanetarias. Bastará únicamente con superar la velocidad de 11.2 km/s para escapar de la atracción gravitatoria terrestre.
En los años 60 las misiones Apolo llevaron al hombre a la Luna, en los 70 los Voyagers iniciaron el más largo viaje jamás hecho por un ingenio fabricado por el hombre, Marte ha sido visitado durante décadas por los Vikings, el Pathfinder y muchos otros, Rosetta se posó en el cometa 67P/Churyumov–Gerasimenko en 2014…
Ante necesidades más sofisticadas, siempre aparecerá un ingeniero aeroespacial que inventará, si se me permite la expresión, una órbita nueva.
Referencias:
[1] Johannes Kepler, "Harmonices Mundi"
[2] Isaac Newton, "Philosophiae Naturalis Principia Mathematica"
José Ignacio González Núñez
Ingeniero Superior de Telecomunicaciones (Universidad Politécnica de Madrid)
Máster en Tecnología Aeroespacial y Telecomunicaciones vía Satélite (UniversityCollege London)
Vicepresidente de Desarrollo de Negocios y Estrategia Regulatoria en Eutelsat Américas
Yo quiero ser Ingeniero de Sistemas y Automática, que afortunadamente es lo que soy, por lo que tengo la gran suerte de hacer lo que me gusta (y que además me paguen por ello 😉. Bueno, además de la Ingeniería de Sistemas y Automática me gusta enseñar, y me gusta investigar, ambas tareas en este maravilloso campo, y es lo que hago como catedrático de Ingeniería de Sistemas y Automática en la Universidad de La Rioja, donde también me dedico a hacer Transferencia, es decir, aplicar los resultados de la Investigación y la Innovación para mejora de los productos y de los procesos productivos (logística, producción, etc.), así como de los servicios (aeropuertos, hospitales, etc.). Por eso cuando Quintín me propuso hacer este capítulo acepté encantado, para poder orientar a todos los jóvenes que lo deseen en lo que consiste esta disciplina de la ingeniería y en lo que podrán hacer si optan por ella.
Todo lo que he adelantado que hago, no lo realizo yo solo, pues hoy en día un ingeniero que trabaje solo no puede competir ni puede avanzar al ritmo de los que trabajan en grupo, y por tanto lo que aquí os digo que hago en realidad no lo hago yo, sino que lo hacemos mi grupo. Y de nuevo me considero afortunado al contar con un grupo de amigos que trabajamos juntos, es decir, que además de trabajar en lo que nos gusta lo hacemos con quienes nos gusta hacerlo.
Lo que acabo de contar, no lo he hecho porque quiera "contar mi vida", sino porque de ello se desprenden muchas ideas muy importantes sobre nuestro propósito. Algunas ya están adelantadas, como que el trabajo en equipo es fundamental, como lo es tener un buen ambiente de trabajo, tanto en la Ingeniería de Sistemas y Automática, como en la Ingeniería en general, como en cualquier trabajo. Pero hay otra idea oculta en todo ello que es la base de la Ingeniería de Sistemas: un sistema es un conjunto de elementos que se relacionan entre sí constituyendo una entidad que no es simplemente la suma de sus elementos.
Bueno, he dado una definición un poco rigurosa, y como Quintín me pidió que el capítulo fuese informal y directo para futuros científicos 😉 de ahora 14 a 18 años, voy a tratar de explicarlo de otra manera, y además voy a hacer referencia únicamente en este capítulo a las redes sociales (en lo que esos chicos de 14 a 18 años son mucho mejores que yo), y en concreto a la Wikipedia.
Supongamos que tenemos una caja con un cerebro (de un conejo por ejemplo, para no ser muy macabro), un hígado, unos riñones, unos cuantos litros de sangre, etc. Es decir, los elementos que constituyen el sistema que es el conejo. Por separado el cerebro no puede hacer nada, y de hecho muere en poco tiempo, como lo hace el resto de elementos sin el cerebro, o sin el hígado, etc. Pero todos juntos, y debidamente relacionados, constituyen un Sistema, y además un sistema fantástico, pues es un ser vivo. Lo mismo podríamos pensar con el disco duro, el teclado, la CPU, la memoria, etc. de nuestro ordenador, o con sistemas muy muy complejos, como puede ser los fenómenos atmosféricos y meteorológicos, los entornos naturales y los ecosistemas, etc.
Pues bien, entender las relaciones entre las partes que componen los sistemas y entender el comportamiento del sistema completo es la base de la Ingeniería de Sistemas. Voy a poner un par de ejemplos:
-Supongamos un modelo muy simple de un entorno natural en el que hay zorros y hay conejos. Tanto unos como otros se reproducen a un cierto ritmo, dependiendo del número de parejas de su especie que haya. Por otro lado, como los zorros se alimentan de conejos, cuantos más conejos haya más va a crecer la población de zorros, pero cuantos más zorros haya más va a decrecer la población de conejos. Se trata de un sistema muy simple, con sólo dos elementos (un depredador y una presa), y unas pocas relaciones entre ellos. Y sin embargo la evolución del sistema es muy compleja, con variaciones cíclicas de las poblaciones en unos casos, o la desaparición de los conejos y luego de los zorros, o la desaparición sólo de los zorros, dependiendo de los valores iniciales y del tipo de relaciones concretas que definamos. Ese análisis lo realizaron ¡hace menos de un siglo! de manera independiente dos matemáticos, Alfred J. Lotka en 1925 y Vito Volterra en 1926, y se conoce como Las ecuaciones de Lotka-Volterra o las ecuaciones predador-presa.
-Más tarde todavía (para que veáis lo reciente que es esta disciplina), otro ingeniero, Jay Wright Forrester (1918-2016) se dio cuenta de que en un simple almacén con mercancías almacenadas para vender, empleados, y clientes, con unas relaciones muy simples se producían unas oscilaciones similares en el número de empleados y el producto almacenado, y lo plasmó en el célebre libro Industrial Dynamics (en 1961, ayer mismo como quien dice), considerado el origen de la dinámica de sistemas, de la que Forrester es considerado el padre.
La dinámica de sistemas busca los elementos que componen los sistemas, analiza las relaciones entre ellos (especialmente buscando ciclos de relaciones) y determina de qué tipo será la respuesta. Para ello emplea diagramas causales, que después se depuran en diagramas de Forrester, y finalmente se transforman en ecuaciones para analizarlas (eso ya hoy en día lo hacen muy bien las aplicaciones informáticas).
Por ejemplo, un ingeniero de sistemas puede determinar de esta manera cómo evolucionará una epidemia (pongamos que de gripe) en la población, en la que habrá personas sanas (sin contagiar), personas contagiadas, personas que ya se han curado y por tanto están inmunizadas, etc. Así que cuando oigamos por los medios de comunicación que se espera un descenso de la incidencia de une epidemia con un repunte posterior, además de médicos seguro que hay un ingeniero de sistemas que ha analizado la evolución de la epidemia y ha generado un modelo para determinar su dinámica.
Por eso la ingeniería de sistemas está hoy en día relacionada con la disciplina conocida como Modelado y Simulación, consistente en eso mismo, modelar las partes del sistema y sus relaciones, simularlo computacionalmente, y determinar el comportamiento. Y eso se emplea en cualquier campo de la ingeniería: comportamiento del viento en lo aerogeneradores, comportamiento de las aeronaves y su capacidad de vuelo, determinación de movimientos de personas, equipajes y aviones en un aeropuerto, etc.
Un ejemplo muy divertido es el "juego de la cerveza" (the beer game), que simula la producción y venta de una fábrica de cerveza, y muestra la dificultad que tiene hacer los pedidos de varios puestos intermedios sin llevar la fábrica a la ruina. Y todo ello está relacionado con la automática como veremos. En realidad el término automática comprende dos cosas diferenciadas: la Ingeniería de Control y la Automatización Industrial.
La Ingeniería de Control lo que hace es, no sólo determinar el comportamiento de un sistema, sino la forma de controlarlo para que su comportamiento sea el adecuado. Es decir, se diseñan y desarrollan "controladores" y algoritmos de control, que son los encargados de hacer que el sistema se comporte como deseamos. Se basan en conocer el comportamiento, compararlo con el que queríamos, y determinar la acción de control necesaria en cada momento. Por ejemplo un avión no podría volar como lo hace sin un sistema de control automático, y mucho menos una nave espacial, pero también sistemas tan sencillos como motores, aires acondicionados, amortiguación activa de los coches, etc. emplean controladores.
Por otro lado la automatización Industrial lo que hace es emplear sistemas o elementos computarizados y electromecánicos para controlar maquinarias y procesos industriales, incluyendo robótica, visión artificial, y técnicas de inteligencia artificial para la toma de decisiones.
Es evidente la relación directa que todo ello tiene con la nueva revolución industrial, la cuarta revolución industrial o Industria 4.0, también conocida como la de los sistemas ciberfísicos, que tenemos ya a la vuelta de la esquina, y que va a cambiar el mundo (no sólo la producción y el trabajo sino toda la sociedad) en muy pocos años.

Por eso, como resumen, no puedo deciros que si decidís como yo haceros ingenieros de sistemas y automática vayáis a trabajar con robots, visión artificial, sistemas inteligentes de producción, modelado y simulación, regulación automática, o analizando, comprendiendo y controlando sistemas complejos de cualquier tipo, porque en pocos años, muy pocos, lo que van a hacer los Ingenieros de Sistemas y Automática es adaptar los sistemas productivos a la Industria 4.0, para lo que ADEMÁS de todo lo anterior trabajaréis con Big Data, Realidad Aumentada, Cloud Computing, Robótica colaborativa, Internet de las Cosas, etc., es decir, las disciplinas en las que se basa la Industria 4.0.

Como ejemplo, cuelgo unas imágenes de algunos de nuestros trabajos en esas líneas: Un simulador de robótica colaborativa (desarrollado como proyecto fin de carrera por el mejor estudiante que he tenido, ahora ya compañero) y dos plantas industriales en las que hemos sido capaces de aplicar los conceptos de Industria 4.0, y desarrollarlas plenamente de manera virtual, antes de que ese concepto se pusiese en marcha.

Es el futuro, que ya está aquí, y es lo que tendréis que hacer en este oficio.
Emilio Jiménez
Doctor Ingeniero Industrial
Universidad de la Rioja
Yo quiero ser Ingeniero Eléctrico, aunque tengo que reconocer que los ingenieros en ramas industriales solemos ser más ingenieros que especialistas, en este caso en ingeniería eléctrica. Y como prueba, mis estudios comenzaron con Ingeniería Técnica Industrial en Ingeniería Electrónica y Automática, que se supone que era mi especialidad cuando concluí Ingeniería Industrial, aunque mi Tesis doctoral la orienté a lo que acababa de ser mi comienzo profesional, la energía eléctrica producida por molinos eólicos. Y así me convertí, profesionalmente, en Ingeniero Eléctrico y especialista en energías renovables, sobre todo energía eólica.
Y como es una profesión apasionante, y con un futuro muy prometedor, quiero contribuir a este trabajo con un capítulo en el que transmitiros lo más interesante que tiene y lo que os puede esperar si elegís este camino.
Comencemos con una definición de los que es ingeniería eléctrica, para lo que voy a permitirme copiar los 2 primeros párrafos de la Wikipedia, Ingeniería Eléctrica, que lo resumen muy bien, y posteriormente los matizaré en base a mi experiencia personal y profesional:
"La ingeniería eléctrica es el campo de la ingeniería que se ocupa del estudio y la aplicación de la electricidad, la electrónica y el electromagnetismo. Aplica conocimientos de ciencias como la física y las matemáticas para diseñar sistemas y equipos que permiten generar, transportar, distribuir y utilizar la energía eléctrica.
Dicha área de la ingeniería es reconocida como carrera profesional en todo el mundo y constituye una de las áreas fundamentales de la ingeniería desde el siglo XIX con la comercialización del telégrafo eléctrico y la generación industrial de energía eléctrica. Dada su evolución en el tiempo, este campo ahora abarca una serie de disciplinas que incluyen la electrotecnia, la electrónica, los sistemas de control, el procesamiento de señales y las telecomunicaciones."
Como sabéis la energía ha ido siempre ligada al desarrollo del ser humano. El control del fuego puede considerarse uno de los elementos distintivos de la humanidad, si no el que más, y básicamente consiste en controlar energía que puede liberarse rápidamente para conseguir altas temperaturas, que permitió no sólo alimentarse mejor, o defenderse de depredadores más grandes, o combatir las inclemencias del tiempo, sino comenzar el desarrollo de la tecnología, en la edad de los metales, pudiendo fundir el metal, y obtenerlo en mucha mayor cantidad que simplemente maleando las escasas piezas de metal natural.
Posteriormente (muy posteriormente), el control de la energía para conseguir que gire un mecanismo (con la máquina de vapor) constituyó la primera revolución industrial, al poderse emplear energía de la naturaleza (carbón o madera) en la fabricación mediante máquinas conectadas a esa máquina de vapor. Ello supuso una revolución industrial, pero sobre todo social, que originó el comienzo del crecimiento de la población y de la sociedad urbana predominante actual.
La siguiente revolución industrial también tiene mucho que ver con esta profesión, pues se basó en la electricidad. Ahora ya no sólo se podía emplear la energía natural en la fabricación, sino que además podía trasladarse esa energía a grandes distancias de manera inmediata y muy barata, simplemente con cables metálicos. Ya no era necesario trasladar grandes cantidades de carbón o poner las fábricas cerca de las fuentes de energía, sino que bastaba con conectar las fábricas y las ciudades con los centros de obtención de energía, mediante líneas eléctricas. A todos los que os guste este campo os recomiendo leer la biografía de Nikola Tesla, e irremediablemente os convertiréis en apasionados de su trabajo y de la energía eléctrica. También es interesantísima su relación antagónica con Edison, tanto en cuestiones técnicas (corriente continua frente a corriente alterna) como en su concepción de la vida (idealismo frente a pragmatismo).
Posteriormente ha habido una tercera revolución industrial, basada en la informática y la robótica, que aunque no sea tan evidentemente también ha tenido mucho que ver en esta profesión, pues gracias a los desarrollos electrónicos es posible que los molinos eólicos sean más eficientes, puedan conectarse a la red casi sin limitaciones (hace pocos años no era posible porque producían inestabilidades), e incluso se ha llegado a que en muchos ámbitos es más conveniente el transporte de energía eléctrica en corriente continua que en corriente alterna, lo cual era absolutamente imposible en tiempos de la segunda revolución industrial.
Actualmente estamos en puertas de la cuarta revolución industrial, la de los sistemas ciberfísicos, que casi sin darnos cuenta está llegando a nuestra sociedad, y sin duda también será clave en esta profesión.
Muchos de los que os dediquéis a la generación y transporte de energía eléctrica lo haréis trabajando en dispositivos para teléfonos inteligentes que permitan optimizar el consumo y la distribución, pero especialmente parece ser que la cuarta revolución industrial está llegando al sector con el desarrollo de las mini y micro redes aisladas, para edificios, o para poblaciones, tendiendo hacia la generación renovable y el autoconsumo, junto a una utilización inteligente de la energía para minimizar el impacto ambiental.
Tanto en las futuras redes de autoconsumo, como en las grandes redes eléctricas existentes en la actualidad, se integran además de los consumidores (fábricas y hogares), los diferentes productores de energía eléctrica: centrales térmicas y de ciclo combinado, centrales nucleares, centrales hidráulicas, parques eólicos y solares, etc.

Fig. 3. Líneas eléctricas de distribución. By Vincent van Zeijst (Own work) [CC BY-SA 3.0], via Wikimedia Commons
Y los ingenieros eléctricos nos encargamos de la generación de esa electricidad y su distribución, aunque como veis hay una rama profesional muy cercana, que es la de los ingenieros energéticos, que tratan además de esas fuentes de energía que producen electricidad, las fuentes que producen calor (como la termosolar, la energía de la biomasa, geotérmica, etc.).
En resumen, podríamos considerar que las labores que os corresponderán como ingenieros eléctricos a los que elijáis este camino, incluyen entre otras:
-Producción de energía eléctrica: diseñar, instalar, mantener y optimizar sistemas de producción de energía eléctrica a partir de las diferentes fuentes de energía: hidráulica, fósiles (carbón, petróleo, y gas natural), nuclear, solar (fotoeléctrica o fototérmica), eólica, etc.…
-Transporte de energía eléctrica: diseñar, instalar, mantener y optimizar los sistemas de transformación, transmisión y distribución de energía eléctrica.
-Análisis de sistemas eléctricos: modelar, analizar, evaluar, y optimizar los sistemas y equipos que intervienen en las fases de producción, consumo, y transporte de la energía eléctrica.
-Investigar la mejora de sistemas de almacenamiento de energía eléctrica.
-Control, protección, medición y optimización de sistemas eléctricos en sus diferentes fases de producción, transporte y consumo.
-Análisis de la demanda y adaptación a los sistemas técnicos y a las mejores opciones de comercialización de energía eléctrica.
-Mejora de la eficiencia energética en los sectores residencial e industrial
-Optimización de la integración en red de sistemas distribuidos de producción y de los consumos
-Adaptación de los sistemas eléctricos a las nuevas tecnologías de la información y las comunicaciones y a los sistemas ciberfísicos basados en las tecnologías de la Industria 4.0.
Os adjunto finalmente 4 imágenes, de Wikipedia, de instalaciones en las que es frecuente encontrar ingenieros eléctricos. Hubiese puesto más, como centrales hidráulicas o de ciclo combinado, pero me han pedido no extenderme demasiado, así que ahí lo dejo, pero quedo a disposición de quien quiera consultarme cualquier cuestión adicional.
Eduardo Martínez Cámara
Doctor Ingeniero Industrial
Grupo Energías Renovables, Universidad de la Rioja
Un ingeniero en Fluidomecánica se encarga de estudiar y aprovechar, en beneficio propio, el movimiento de los fluidos, las fuerzas inducidas por ese desplazamiento y el intercambio de energía asociado a él. La rama de la física que fundamenta esa rama de la ingeniería es la Mecánica de Fluidos y engloba tanto a líquidos como a gases. Creo que no existe ese título para definir a ningún ingeniero, pero la especialidad y la asignatura sí que se imparte, bajo diferentes nombres, en distintos títulos de grado de todas las escuelas de Ingeniería de España. Un ejemplo cercano es la asignatura de "Ingeniería Fluidomecánica" de la Universidad Carlos III de Madrid, donde imparto clase, y que se imparte en varios títulos de grado.
El agua y el aire han sido los fluidos más usados por el hombre. Existen evidencias históricas que sugieren la utilización de molinos de agua en la India en el siglo IV a. de C. Su importancia práctica y filosófica en el antiguo Egipto, Grecia y Roma es indudable. En el Renacimiento, Leonardo da Vinci, Torricelli, Pascal y Newton hicieron aportaciones importantes en el estudio de los fluidos. Sin embargo, durante siglos, todo avance tecnológico relacionado con el uso de los fluidos para la realización de un trabajo útil estuvo basado en el método de ensayo y error y era, por lo tanto, lento e impreciso. Para la cimentación de los fundamentos matemáticos de esa ciencia tendríamos que esperar al el matemático suizo Leonard Euler, al ingeniero francés Claude-Louis Navier y al físico y matemático irlandés George Gabriel Stokes.
En su trabajo original, que hacía uso de las aportaciones de otros científicos, Euler escribió las ecuaciones sin tener en cuenta el efecto de la viscosidad del fluido. Navier y Stokes si incluyeron los esfuerzos viscosos en las ecuaciones de Euler para, finalmente, escribir las que a la postre se denominaron ecuaciones de Navier-Stokes (NS de aquí en adelante): un conjunto de tres ecuaciones diferenciales en derivadas parciales que, junto a la ecuación de continuidad, permite obtener las tres componentes de la velocidad y la presión del fluido. Las ecuaciones de NS son esencialmente una nueva forma de escribir la tercera ley de Newton en las que la variación de la cantidad de movimiento es igual a la suma de las fuerzas que actúan sobre el fluido. A diferencia de los cuerpos sólidos, los fluidos se deforman bajo el efecto de las fuerzas, modificando su forma y, a veces, algunas de sus propiedades. Estas particularidades, que se derivan de la organización molecular de los fluidos, complica sustancialmente la descripción de su movimiento.
Esos tres científicos arriba mencionados redujeron el movimiento de un fluido a un problema de análisis matemático, ¡pero qué problema! Resolver las ecuaciones de NS es tan complicado que constituye uno de los siete problemas del milenio propuestos por el Clay Mathematics Institute y por los que pagará un sustancioso premio de un millón de dólares a quien logre obtener la solución general de las ecuaciones. Durante gran parte del siglo XX se avanzó poco en ese objetivo. La dificultad radica en el comportamiento aparentemente impredecible y caótico que muestra el movimiento de los fluidos debido, fundamentalmente, a la sensibilidad extrema del mismo a las condiciones iniciales: dos sistemas con condiciones iniciales casi idénticas dan lugar a soluciones que, rápidamente, divergen en dos soluciones sin relación aparente.
Puesto que las matemáticas no permiten integrar exactamente las ecuaciones de NS, la mecánica de fluidos ha utilizado los ordenadores de forma intensiva para resolver las ecuaciones mediante técnicas numéricas. Aunque siempre introducen pequeños errores en la solución final, las soluciones numéricas pueden llegar a ser muy precisas. Gracias a los ordenadores somos capaces de realizar multitud de operaciones matemáticas simples (sumas, restas, multiplicaciones y divisiones) en muy poco tiempo. La potencia de cálculo de los computadores se mide en FLOPS (operaciones en coma flotante por segundo que son capaces de realizar). Por poner un ejemplo, podemos estimar que un ordenador de sobremesa, como el que podamos tener en casa, realiza del orden de 109 operaciones por segundo. El mayor ordenador de España, el MareNostrum4, alojado en el centro de Supercomputación de Barcelona, tiene, desde su actualización en Julio de 2017, una potencia pico de 11.15 PetaFlops o, lo que es lo mismo, es capaz de realizar 13,000,000,000,000,000 (trece mil trillones o 1015) operaciones por segundo.
Cuando un niño aprende a escribir, para enseñarle el trazado de las letras, se disponen una serie de puntos sobre una lámina de papel para que, después de unir todos los puntos mediante rectas, obtenga la letra buscada. De forma parecida, la mecánica de fluidos computacional calcula la presión y las tres componentes velocidad en ciertos puntos del espacio y, después, imitando la técnica de los niños de unir esos puntos, conforma la descripción continua de los campos de velocidad y presión. Esos puntos forman la malla computacional, como se denomina en la jerga del oficio. Lógicamente, cuanto más complicado es el movimiento del fluido o mayor precisión en la descripción del mismo se requiera, más puntos necesitamos, lo que a su vez implica un mayor coste a la hora de llevar a cabo ese cálculo.
De forma general, las características del movimiento de un fluido depende del valor del número de Reynolds, definido como Re= ρuclc/μ, siendo ρ la densidad y μ la viscosidad del fluido, uc la velocidad característica del fluido y lc una longitud características del problema a estudiar. El parámetro Reynolds es un número sin dimensiones y mide la importancia relativa entre las fuerza de inercia ρu2c /lc y la de viscosidad del fluido μuc/l2c. Si el número de Reynolds es pequeño, la viscosidad del fluido domina el movimiento y decimos que éste se encuentra en régimen laminar. Como indica su nombre, en este régimen el movimiento del fluido se ordena en capas paralelas, como si fueran láminas que deslizan en la misma dirección una sobre otra, con la viscosidad actuando como mecanismo de disipación de energía.

Fig. 1. Escalas características para el flujo sobre un perfil NACA-0012 con Re=50.000. La figura de arriba presenta niveles de turbulencia menores que la figura de abajo [1]. Las líneas azules representan el vector velocidad antes de llegar al perfil y sobre él.
Para valores grandes del número de Reynolds, el movimiento deja de ser ordenado para formar un flujo medio sobre el que se superponen un gran número de vórtices y de remolinos que giran. El flujo medio tiene una velocidad um a la que se añaden oscilaciones de velocidad u’ inducidas por esos vórtices y remolinos. El tamaño del menor de estos torbellinos η es función del valor del Re, siendo menor cuanto más grande es el número de Reynolds y mayor es el nivel de turbulencia. Su tamaño se relaciona con la longitud característica a través del número de Reynolds lc/η = Re3/4. Es en esas escalas más pequeñas donde la viscosidad del fluido se hace dominante disipando la energía almacenada en el fluido. Como se indica en la Fig. 1, es común que un flujo laminar se inestabilice y se transforme en uno turbulento. Para complicar las cosas todavía un poco más, flujos con igual valor del número de Reynolds pueden presentar distintos valores de turbulencia debido, por ejemplo, a factores que amplifican las oscilaciones de velocidad (por ejemplo, la rugosidad del material).
Un ejemplo de integración numérica de las ecuaciones de NS se puede ver en la Fig. 1, donde se muestran los resultados de los cálculos llevados a cabo por Jones et al [1] para un flujo con Re=5x104 basado en la velocidad a la que el fluido se acerca al perfil U∞ y en la cuerda del mismo c. Basados en ese ejemplo podemos concluir que para describir numéricamente un flujo laminar, como el que se desarrolla cerca del borde de ataque del álabe de la Fig. 1, necesitamos mallas computacionales con puntos suficientes para describir cambios en la velocidad en una región de tamaño característico lc ~ c, pero para un flujo turbulento necesitamos que la distancia entre los puntos de nuestra malla sea de orden η<<lc. Al ser esa distancia entre puntos mucho más pequeña, será necesario disponer de muchos más y el cálculo será más costoso.
A partir de las estimaciones hechas más arribas, podemos anticipar que el número de puntos necesarios para integrar numéricamente uno de estos flujos turbulentos crece como N ~ Re9/4. Consideramos, por ejemplo, la avioneta Air Tractor 802F que se usa en labores de extinción de incendios todos los veranos en España. Este pequeño avión tiene un ala de cuerda lc = c = 1 m, un perfil semejante al mostrado en la Fig. 1 y se desplaza por el aire a baja altura con una velocidad de crucero de unos uc=300 km/h=83 m/s. Usando los valores de densidad y viscosidad del aire a nivel del mar, tenemos valores del número de Reynolds del orden de Re= 1.38 x 105. Para obtener la velocidad y la presión en una porción del ala de ese avión de 1 m² tendremos que integrar numéricamente las ecuaciones de NS. Si lo hacemos en un ordenador de sobremesa doméstico, ese cálculo llevaría 1013 s o 317.100 años. Para el mayor ordenador de España, el Marenostrum 4 necesitarías esperar 107 s, poco más de 4 meses. Si tenemos en cuenta el área total del ala de la avioneta es 18 m², rápidamente nos damos cuenta de que cálculos como el descrito en el párrafo anterior son, de momento, inasumibles tanto por el tiempo de cálculo que necesitan como por el tamaño descomunal de la información generada que hay que almacenar para su posterior análisis.
El cálculo de flujos industriales, con valores de Re mucho mayores al del ejemplo, es todavía una utopía y no se espera que podamos abordarlo hasta, al menos, dentro de un siglo. Y eso si la potencia de cálculo continua creciendo al mismo ritmo que lo hace actualmente, es decir, multiplicando el número de operaciones por segundo por un factor 10 cada siete años. La disponibilidad de los recursos computacionales para integrar las ecuaciones es una condición necesaria, aunque no suficiente. Las técnicas para la integración de las ecuaciones son complejas y su implementación en códigos requieres de años de estudio y dedicación. Además, hay que tener en cuenta que proceso de cálculo arriba descrito es la parte más sencilla del proceso de diseño. Posteriormente, es necesario analizar con mucho detalle todos esos datos para extraer conclusiones útiles tanto desde el punto de vista científico como técnico e ingenieril. Y ahí es donde el ingeniero es la clave, no hay ordenador que interprete los resultados obtenidos a partir de la integración de las ecuaciones.
Conocedores de esas limitaciones, ingenieros y científicos han obtenido resultados más que notables mediante aproximaciones y modelos con los que, pese a no conocer los detalles de la turbulencia, han hecho volar a los aviones y girar a las turbinas eólicas, han predicho el tiempo y navegar a los aviones. Hoy en día hay multitud de códigos comerciales que permiten integrar las ecuaciones de NS con poca formación previa. Sin embargo, esos códigos usan aproximaciones y técnicas numéricas que arrojan unos resultados que deben usarse con cautela por parte de los usuarios para evitar llegar a conclusiones de poca validez física. En el último siglo, nuestro conocimiento de la mecánica de fluidos ha crecido gracias a modelos simplificados de problemas complejos que se fundamentaban en hipótesis que se validaban, después, experimentalmente. La disponibilidad de recursos computacionales no debería modificar la secuencia que acabamos de describir y que es aplicación directa del método científico. Todo cálculo numérico debería estar soportado en la teoría ya que, de lo contrario, corremos el riesgo de reducir la práctica del ingeniero fluidomecánico a la creación de coloridos gráficos que nadie entiende y que nada representan.
Un ejemplo de buena práctica fue la misión Apolo 11 con la que se llegó a la Luna por primera vez en 1969. Los ordenadores usados para los sistemas de guiado de las naves tenían una capacidad de cálculos de entorno a las 85.000 operaciones por segundo. Hoy, un teléfono iPhone 7 es capaz de realizar 172.000.000.000 operaciones por segundo, más de dos millones de veces más capacidad de cálculo que los ordenadores del Apollo 11, que se usan, excepto excepciones, para mandar mensajes de texto o para consultar alguna que otra página web.
Referencias:
[1] L. E. Jones,R. D. Sandberg, N. D. Sandham, Journal of Fluid Mechanics, 602 (2008) 175-207.
[2] J. Jiménez, Journal of Turbulence 4 (2003) Paper 22.
Mario Sánchez Sanz
Doctor en Ingeniería Matemática, Profesor titular.
Departamento Ing. Térmica y de Fluidos, Universidad Carlos III de Madrid
Capítulo 96
Y yo quiero ser...Ingeniero Industrial (Tecnologías Energéticas)
(Por José Ramón Sánchez Moreno)
Y yo quiero ser...Ingeniero Industrial (Tecnologías Energéticas)
(Por José Ramón Sánchez Moreno)
Desde luego no es fácil decidir aquello a lo que queremos dedicar nuestra vida profesional. En ocasiones la decisión se produce de forma repentina, quizás tras una magistral exposición por parte de un profesor de una materia que despierta nuestra atención y en otras ocasiones no se produce de forma tan evidente, sino que requiere analizar esos aspectos cotidianos que nos hacen sentirnos realizados.
En mi caso fue durante mi infancia donde siempre me habían atraído los objetos que pudieran montarse y desmontarse. Me fascinaba poder entender el modo como encajaban las piezas, porqué alguien había decidido esas formas para unir las piezas, el modo en el que todas juntas conformaban un elemento plenamente funcional. Ese interés por entender el funcionamiento de todo lo que me rodeaba, de tener la capacidad de decidir cómo combinar los diferentes materiales para crear un dispositivo fue lo que me llevó a cursar estudios de Ingeniería Industrial.
Una carrera multidisciplinar con un gran número de especialidades que permite entender el funcionamiento de sistemas, máquinas e instalaciones que nos rodean. De entre todas las especialidades que esta carrera permite elegir, de modo que queden cubiertas todas las tecnologías de que disponemos hoy en día en cualquier máquina o dispositivo, elegí la de Tecnologías Energéticas por incluir todas aquellas disciplinas relacionadas con la producción y aprovechamiento de la energía con especial énfasis en la eficiencia energética.
Y es que la búsqueda del mínimo consumo resulta en muchos casos un reto mayor y más complejo que descubrir un nuevo dispositivo o maquinaria que facilite nuestro trabajo. Y para mí este campo despertó una gran admiración y un gran interés en colaborar para desarrollar y contribuir a dar a conocer sistemas que consuman cada vez menos energía. La búsqueda del móvil perpetuo es para muchos una aventura comparable a la búsqueda del Santo Grial. Encontrar la máquina u objeto capaz de moverse o funcionar sin apenas energía es un descubrimiento que sin duda revolucionaría el mundo y contribuiría de forma importante a reducir el impacto medioambiental que el consumo de energía tiene inevitablemente en nuestro mundo con unos recursos cada vez más limitados y donde hoy ya nadie duda de los efectos que el cambio climático tiene en nuestro planeta. No en vano, reducir el consumo energético es una preocupación mundial hacia la que la comunidad internacional está dando importantes pasos a través de acciones y políticas como el Protocolo de Kyoto o la apuesta 20/20/20 de la UE.
De modo que aunque por progreso y avance tecnológico muchos puedan entender el descubrimiento de máquinas y mecanismos que hagan nuestra vida más cómoda como medios de transporte más rápidos, sistemas de comunicación globales, sistemas de control integrados, etc. Por progreso también ha de entenderse el conseguir un estado de bienestar e industrialización dentro de una sociedad con el mínimo consumo e impacto ambiental que no ponga en peligro los limitados recursos del planeta. Y es que no es entendible considerar como verdadero progreso disponer de hogares con sistemas domóticos que permiten hoy en día interconectar todas las instalaciones de una vivienda como los sistemas de climatización, iluminación, seguridad e incluso electrodomésticos si la factura eléctrica a pagar por ello es prohibitiva o si el aislamiento de la vivienda no es el adecuado y estoy enfriando o calentando el exterior o trasmitiendo ruidos a los vecinos ¿Se puede entender esto como progreso? Yo creo que no.
Es por esta razón por la que desde hace tiempo tengo la oportunidad de trabajar en el campo de las instalaciones en edificios donde tan importante como elegir los equipos de climatización y calefacción más adecuados en coste y funcionalidad según el uso del edificio (residencial, hospitalario, de trabajo, de ocio, etc.), igualmente importante resulta que esa energía empleada en enfriar o calentar un fluido, y como resultado una edificación, no se pierda a través de ésta.

De nada sirve invertir dinero en la última tecnología de producción de frío o calor, en la más potente y eficiente del mercado, si ese frío o calor se pierde al exterior.
Y es aquí donde cobran gran protagonismo los aislamientos. A veces los grandes infravalorados por su sencillez, pero de una importancia enorme al mantener la temperatura de una habitación o de una conducción y evitando emplear energía de más en cubrir las pérdidas. Aislamientos tan importantes como los que se colocan en fachadas que impiden transmisiones de energía al exterior por conducción de entre los que destacan las lanas minerales como la fibra de vidrio y la lana de roca, los poliestirenos, las espumas elastoméricas, con unas resistencias a la trasmisión de energía importantes. Aislamientos también presentes en las conducciones de fluidos refrigerantes en forma de coquillas o mantas que permiten el transporte de un fluido atemperado bien agua, refrigerante o aire, reduciendo la pérdida de energía ocasionada en el transporte. O vidrios y ventanas de nueva construcción, como los vidrios dobles cuya cámara interior de aire actúa como un gran aislante, o la nueva generación de ventanas en PVC o metálicas con rotura de puente térmico con unos niveles de conductividad térmica muy inferiores a las típicas ventanas correderas que tan profusamente se han ido aplicando en la construcción de viviendas por su bajo coste, y que sin duda han contribuido a un despilfarro de energía por su baja hermeticidad y su estructura enteramente metálica. Todo un error constructivo en una época en la que solo se miraba el precio y que hoy se paga con facturas de gas y electricidad desorbitadas. Errores que afortunadamente las administraciones y organismos preocupados por el uso racional de la energía han ido corrigiendo en los últimos años con la adopción de nuevas normativas como el Código Técnico de la Edificación (CTE) en su versión HE de ahorro de energía que garantiza en las nuevas construcciones y reformas, limitar el consumo energético (no en vano la edificación consume el 40% de la energía), mediante la obligatoriedad de instalación de unos mínimos aislamientos y de unos equipos de producción térmica eficientes apoyados por fuentes de energía renovables como paneles solares térmicos y fotovoltaicos.

Los cuales contribuyen de forma notable a dar cumplimiento a la directiva 2010/31/UE que pretende certificar edificios de consumo casi nulo para 2018 en el caso de edificios públicos y 2020 para edificios de uso privado. Hasta entonces disponemos actualmente de la certificación energética de edificios (por imperativo de la Directiva 2002/91/CE) que mediante etiquetas similares a las utilizadas en los electrodomésticos, permite a los inquilinos prever el gasto energético que sus edificaciones tendrán.
No solo se busca con esas medidas reducir las pérdidas de energía y garantizar el máximo aprovechamiento de los recursos energéticos disponibles. Hoy en día se están haciendo importantes avances en la edificación en soluciones que buscan igualmente reducir el consumo de un bien tan importante como es el agua. Todos somos conscientes de lo limitados que son los recursos hídricos en nuestro país y nuestra fuerte dependencia en la climatología. De modo que además de medidas de ahorro de agua como el uso de aireadores en grifos, últimamente se están aplicando medidas de ahorro de agua sobre el elemento de más consumo de agua en los edificios como son los inodoros. Y pese a que los nuevos inodoros de doble descarga permiten importantes ahorros, no cabe duda que aún se produce un consumo importante de agua que además ha necesitado de un proceso de cloración y potabilización solo para ser empleada como limpiador del inodoro. Bien, pues aquí alguien preocupado por ese despilfarro de agua se le ocurrió porqué no utilizar agua reciclada para alimentar el inodoro. ¿Y reciclada de dónde? Ya que traer una red de agua reciclada de las depuradoras sería costosísimo. Mejor, reciclarla en el propio edificio. Hay ya numerosos ejemplos de hoteles, donde se está aplicando una tecnología denominada de aprovechamiento de aguas grises que consiste en recoger el agua de lavabos y duchas/bañeras (agua gris) para filtrarla y tratarla en un depósito instalado en el propio edificio e impulsarla a través de una red independiente a los inodoros. Una sencilla solución, que no supone una gran inversión y sin embargo repercute en una indudable reducción en el consumo de agua del edificio. Un bien, el agua, del que somos tan dependientes y que bien se merece todo esfuerzo por limitar su derroche.
En definitiva, la ingeniería no busca solo hacer la vida más fácil mediante la introducción en la sociedad de dispositivos o máquinas capaces de realizar tareas de ardua ejecución ya sea en los hogares, en las fábricas, de resolver problemas de movilidad, de comunicación o de control a distancia o incluso de garantizar el confort en nuestro propio hogar, también se preocupa de conseguirlo de la manera más eficiente y con el mínimo consumo de energía y recursos. Todos somos conscientes que vivimos en un planeta con recursos limitados y somos responsables de dejarlo en las mejores condiciones para las generaciones venideras. Es por ello que en este mundo todavía queda mucho por hacer en materia de aprovechamiento eficiente de la energía y de los recursos.
Referencias:
[1] www.isover.es
José Ramón Sánchez Moreno
Ingeniero Industrial (Tecnologías Energéticas)
Yo quiero ser Ingeniero Mecánico, y es lo que soy, aunque no os creáis que me parece sencillo explicar lo que hace un Ingeniero Mecánico en general, pues la Ingeniería Mecánica es tan amplia que puede haber varios Ingenieros Mecánicos que hagan trabajos que nada tenga que ver uno con el otro, pero ambos totalmente integrados en esta disciplina.
Y además me alegra ver que el conocimiento popular (Wikipedia) me da la razón en lo amplia que es esta disciplina y la inmensidad de campos que abarca. Nos cuenta esa fuente que (Ingeniería Mecánica):
"La ingeniería mecánica es una rama de la ingeniería que aplica, específicamente, los principios de la termodinámica, mecánica, mecánica clásica, mecánica cuántica, mecánica de fluidos, análisis estructural, estática, dinámica, ecuación diferencial, trigonometría, ciencia de materiales para el diseño y análisis de diversos elementos usados en la actualidad, tales como maquinaria con diversos fines (térmicos, hidráulicos, transporte, manufactura), así como también de sistemas de ventilación, refrigeración, vehículos motorizados terrestres, aéreos y marítimos, entre otras aplicaciones.
Los principales ámbitos generales desarrollados por ingenieros mecánicos incluyen el desarrollo de proyectos en los campos de la ingeniería que tengan por objeto la construcción, reforma, reparación, conservación, demolición, fabricación, instalación, montaje o explotación de: estructuras, equipos mecánicos, instalaciones energéticas, instalaciones y plantas industriales."
Los principales ámbitos generales desarrollados por ingenieros mecánicos incluyen el desarrollo de proyectos en los campos de la ingeniería que tengan por objeto la construcción, reforma, reparación, conservación, demolición, fabricación, instalación, montaje o explotación de: estructuras, equipos mecánicos, instalaciones energéticas, instalaciones y plantas industriales."
He puesto en negrita las ciencias en las que se basa la Ingeniería Mecánica y los campos en los que se aplica, que resume finalmente en el segundo párrafo en una descripción que me parece buenísima sobre lo que es Ingeniería Mecánica, y que me he permitido ampliar y reordenar como "diseño, construcción, reforma, reparación, conservación, demolición, fabricación, instalación, montaje, análisis, optimización o explotación de instalaciones y plantas industriales, estructuras, equipos mecánicos, e instalaciones energéticas, entre otros".
Lo que para mí tiene que quedar muy claro es que la Ingeniería Mecánica se encuadra dentro de la Ingeniería Industrial, junto a las otras dos Ingenierías básicas en esa disciplina, la Ingeniería Eléctrica y la Ingeniería Electrónica y Automática (además de otras oficialmente reconocidas, como la Ingeniería Química o la Ingeniería Textil, aunque para mí ésta última por ejemplo la considero una especificación dentro de la Ingeniería Mecánica). Además hay que tener en cuenta que en España llamamos Ingeniería Industrial a algo totalmente diferente a lo que se entiende por Ingeniería Industrial en otras zonas, como en la mayoría de países de Hispanoamérica, donde está más bien relacionada con la disciplina de administración de empresas o administración de industrias. Pero en este capítulo nos referimos a la Ingeniería Industrial de la que se habla aquí.
Y esa integración de la Ingeniería Mecánica como parte de la Ingeniería Industrial la quiero mostrar con unos ejemplos, para que aquellos de vosotros que optéis por la Ingeniería Mecánica como profesión veáis que casi con total seguridad tendréis que trabajar con Ingenieros Eléctricos, Electrónicos y de Sistemas y Automática, Químicos, o de otras disciplinas que podrían integrarse en las anteriores, como por ejemplo Ingenieros de Materiales, que yo lo considero parte de la Ingeniería Mecánica, aunque por supuesto eso es discutible.
Y como son tantos los ejemplos que se me ocurren de integración de la Ingeniería Mecánica en la Ingeniería Industrial, voy a comentar simplemente los que la web anterior, para no tener más que una referencia en todo este capítulo.
Centrales hidroeléctricas
Como primer ejemplo vamos a pensar en mi fuente de energía preferida, la energía hidráulica.
En una central hidroeléctrica conviven máquinas hidráulicas, turbinas, tuberías, etc. que son sin duda trabajo de ingenieros mecánicos, junto a generadores eléctricos (Ingeniería Eléctrica), sistemas de regulación automática (Ingeniería de Sistemas y Automática), sistemas electrónicos de potencia (Ingeniería Electrónica), etc. Y el trabajo de los Ingenieros Mecánicos incluye tanto el empleo de la dinámica de fluidos para el diseño y optimización de la turbina y de las tuberías, análisis mediante elementos finitos del comportamiento de las piezas que componen la maquinaria, etc.
Motor a reacción
Relacionado con lo anterior están los motores a reacción, que tienen cierta similitud con las turbinas hidráulicas.
En este ejemplo tal vez la Ingeniería Eléctrica no tenga tanto peso, pero en cambio la Ingeniería Química tiene un papel fundamental en combinación con la Ingeniería Mecánica. Yo en realidad más que de la turbina me centro en el propio motor a reacción. Pero al igual que los motores a reacción, cualquier motor de explosión es puramente Ingeniería Mecánica junto a Ingeniería Química, y similarmente a un avión, un coche (ya sea un turismo o un coche de competición) integra junto a ellas Ingeniería de Sistemas y Automática, Ingeniería Electrónica, Ingeniería Eléctrica, etc. Existen varios ejemplos de aeronaves o de coches totalmente despiezados en aplicaciones informáticas de diseño mecánico, que podéis encontrar en internet, realmente espectaculares, con cientos de miles de piezas y hasta por encima de un millón.
Trasbordador espacial
Aunque hemos comentado los aviones como representantes del sector aeroespacial, y tal vez un buque sería más equitativo en cuanto a la grandísima importancia del sector naval en la Ingeniería Mecánica, considero que el ejemplo del trasbordador espacial merece la pena comentarlo como uno de los mayores hitos de la Ingeniería en general, en los que la Ingeniería Mecánica es una de las fundamentales por la diversidad de materiales críticos empleados, las prestaciones mecánicas requeridas a todas las piezas para soportar las presiones y fuerzas tan tremendas sin comprometer el peso, el análisis aerodinámico del comportamiento de todos los sistemas, etc.

Fig. 3. Trasbordador espacial. Crédito: De User:FEXX, from NASA photo. – NASA, Dominio público 1 , Dominio público 2,
Por no contar la gran estructura necesaria para el despegue, como puede verse en la fotografía.
Un aspecto fundamental a considerar en la Ingeniería Mecánica es la grandísima evolución que ha tenido en los últimos años con el desarrollo computacional, pasando de cálculos con fórmulas y tablas simplemente hace unos años (cuando yo estudiaba e incluso cuando comencé a trabajar) a potentísimas aplicaciones informáticas en la actualidad, que son ya herramientas fundamentales para el Ingeniero Mecánico.
Pueden destacarse las aplicaciones CAM (ComputerAidedManufacturing) y CAD (ComputerAidedDesign), con las que en diseño, análisis y optimización de sistemas complejos es hoy en día una labor además de muy eficiente, apasionante. Cuando trabajo con ellas, realmente no trabajo, sino que disfruto, como sé que os pasará a muchos de vosotros. En vez de nombrar las que yo suelo emplear, prefiero incluir la lista completa indicada en la web de Wikipedia para evitar discriminar a ninguna, que no es mi intención, aunque para quien quiera conocer mis preferencias respecto a ellas o las ventajas e inconvenientes que veo a cada una sólo tiene que contactar conmigo, que encantado le comentaré.
| ALGOR | Solid Edge | Unigraphics NX |
| ABAQUS | Autocad | Autodesk Inventor |
| ANSYS | CATIA | FLUENT |
| LabVIE | WLS-DYNA | Maple |
| MSC.Adams | MSC.Nastran | Matlab |
| ProE | RADIOSS | SolidWorks |
| Workingmodel | WorkXPlore 3D |
Julio Blanco Fernández
Doctor Ingeniero Industrial
Universidad de la Rioja
Hace ya 75 años, el 2 de diciembre de 1942, tuvo lugar la primera reacción nuclear en cadena auto-mantenida en el Chicago Pile-1 (Fig. 1.), el primer reactor nuclear artificial del mundo, nacía así la era de la energía nuclear.

Fig. 1. Grupo de científicos liderados por Enrico Fermi consiguen la primera reacción en cadena auto-mantenida en la Universidad de Chicago en el Chicago Pile- I.
Muchos han sido los avances desde ese primer reactor nuclear, el principal objetivo de este capítulo es acercar al lector a las nociones básicas de la generación eléctrica, el funcionamiento y tipos de centrales nucleares.
Actualmente, la energía es la fuerza que mueve el mundo. Nuestro estilo de vida y la evolución de nuestra sociedad serían imposibles sin ella. De ella depende, entre otras cosas, la iluminación de interiores y exteriores, calentamiento y refrigeración, transporte de personas y mercancías, la obtención de alimentos y su preparación o el funcionamiento de fábricas...
En una central nuclear se aprovecha el calor generado mediante la fisión del átomo para generar el vapor que moverá la turbina para producir el movimiento de alternadores que transforman dicho trabajo mecánico en energía eléctrica. Habitualmente, las centrales nucleares constan de uno o más reactores.
El núcleo de un reactor nuclear está compuesto por una vasija en cuyo interior se hallan los elementos combustibles formados por material fisible (uranio-235 o plutonio-239). Para moderar la reacción sostenida de fisión se emplea lo que se denomina moderador, generalmente agua aunque también se utiliza gas inerte, que absorbe el exceso de neutrones liberados manteniendo bajo control la reacción en cadena del material radiactivo. Rodeando al núcleo de un reactor nuclear está el reflector cuya función consiste en devolver al núcleo parte de los neutrones que se fugan de la reacción. Para moderar algo más rápido o acelerar el factor de multiplicación del proceso de reacción en cadena del circuito nuclear existen las barras de control, que se sumergen facultativamente en el reactor. Existe un blindaje especial que rodea al reactor para absorber la radiactividad emitida y proteger la instalación y a sus trabajadores.
Tipos de centrales nucleares
Existen muchos diseños diferentes de centrales nucleares en el mundo cada una con sus propias ventajas e inconvenientes. En España hay instalados únicamente dos tipos: centrales de agua a presión (Pressurized Water reactor o PWR) y centrales de agua en ebullición (Boiling Water Reactor o BWR).
-Reactor de agua a presión (PWR)
El reactor de agua a presión es el reactor nuclear más utilizado en el mundo. La característica principal de este tipo de centrales es que poseen tres circuitos diferenciados. En la Fig. 2. se puede observar dichos circuitos además de los componentes principales.

Fig. 2. Esquema de un reactor de agua a presión (PWR)
En el circuito primario se encuentra el reactor. La energía generada por el núcleo del reactor es transportada mediante el agua de refrigeración que circula a gran presión hasta un intercambiador de calor. Esta agua no llega a evaporarse, sino que permanece en estado líquido gracias a que se encuentra a grandes presiones. El presionador es el componente que permite controlar la presión del circuito. Este circuito primario es un circuito cerrado, el agua, que se calienta en el reactor, circula gracias al impulso de unas bombas, pasando por un generador de vapor, donde se enfría y vuelve al reactor.
El circuito secundario es un circuito cerrado, el agua entra en el generador de vapor donde se calienta y se evapora, sin entrar en contacto con el agua del primario. El vapor se introduce en una turbina que acciona un generador eléctrico y se envía a un condensador, donde se enfría y se condensa. El agua condensada es enviada de nuevo al generador de vapor, empezando el ciclo de nuevo.
El último circuito, el terciario, a diferencia de los anteriores, es abierto.
El agua procedente de una fuente externa como el mar, un rio o un embalse se bombea hacia el condensador para enfriar el vapor procedente del generador de vapor del circuito secundario y se devuelve a su origen o a la atmosfera, en forma de vapor de agua, a través de las torres de refrigeración.
-Reactor de agua en ebullición (BWR)
El reactor de agua en ebullición, también se utiliza con frecuencia. A diferencia del PWR, en este tipo de centrales no existen tres circuitos independientes, sino que solo hay dos. El calor generado en el núcleo se utiliza para hacer hervir el agua.

Fig. 3. Esquema de un reactor de agua en ebullición (BWR)
El vapor producido se introduce en una turbina que acciona un generador eléctrico, por lo que no es necesario un generador de vapor, como se observa en el esquema de la Fig. 3. El vapor que sale de la turbina pasa por un condensador, donde se transforma nuevamente en agua líquida. Posteriormente vuelve al reactor al ser impulsada por una bomba.

Fig. 3. Esquema de un reactor de agua en ebullición (BWR)
El vapor producido se introduce en una turbina que acciona un generador eléctrico, por lo que no es necesario un generador de vapor, como se observa en el esquema de la Fig. 3. El vapor que sale de la turbina pasa por un condensador, donde se transforma nuevamente en agua líquida. Posteriormente vuelve al reactor al ser impulsada por una bomba.
Otra diferencia fundamental entre ambos tipos de tecnología es la parte de la vasija por la que se insertan las barras de control en los elementos combustibles. En las centrales tipo BWR se introducen las barras por la parte inferior de la vasija del reactor, mientras que en las centrales tipo PWR se hace por la parte superior.
Centrales nucleares en España
En España existen siete reactores en funcionamiento: Almaraz I y II, Ascó I y II, Cofrentes, Trillo I y Vandellós II. Además de un reactor desconectado: Santa María de Garoña, y dos en proceso de desmantelamiento: Vandellós I y José Cabrera (Zorita).
Entre todas las centrales nucleares españolas se produce una potencia de 7.864,7 MW en 2016, liderando así la producción en el Sistema Eléctrico español al haber producido el 21,39% de electricidad bruta total. En 2016, la producción eléctrica nuclear supuso el 35,18% de la electricidad generada en España, sin emisiones. En España resultan esenciales para la estabilidad del sistema eléctrico al estar siempre disponibles (24 horas 365 días al año). En la última década la energía nuclear viene aportando una quinta parte de la electricidad que consumimos de manera constante, sin intermitencias y libre de CO2.
Existen, además, otras instalaciones nucleares como la fábrica de combustible nuclear en Juzbado, Salamanca y un centro de almacenamiento de residuos radiactivos de baja y media actividad en El Cabril, Córdoba. Además, del proyecto de construcción de Almacén Temporal Centralizado (ATC) en Villar de Cañas, Cuenca, para los de mayor radioactividad.
Otras aplicaciones
La ingeniería nuclear, no solo se refiere a la generación eléctrica, sino a toda aplicación práctica del átomo, desde las técnicas de análisis de datación arqueológica (arqueometría nuclear) hasta las técnicas utilizadas en la medicina nuclear o pilas de mucha duración para sistemas que requieren poco consumo eléctrico. En la Fig. 4. se observan algunos ejemplos de dichas aplicaciones.

Fig. 4. (a) Howard Carter analizando la tumba de Tutankamón (New York Times, 1923); (b) imagen de un cerebro por resonancia magnética nuclear; y (c) ejemplo de pilas nucleares de 20 años de duración.
Conclusiones
La diferencia fundamental entre una central nuclear y el resto de centrales eléctricas, es la fuente para la generación de calor. Mientras que en las centrales térmicas, se usan combustibles fósiles (carbón, gas o petróleo), en las centrales nucleares se aprovecha la inmensa energía existente en los átomos. En las centrales nucleares el calor generado de la fisión del átomo se utiliza para calentar agua y producir vapor. El vapor se convierte en energía mecánica en las turbinas y esta se transforma finalmente en electricidad en el alternador.
La energía nuclear produce una gran cantidad de energía eléctrica, pero también produce residuos nucleares que hay que guardar en depósitos especializados. Aunque la mayor ventaja de todas es que NO produce contaminación atmosférica de gases derivados de la combustión que producen el efecto invernadero, ya que no precisan del empleo de combustibles fósiles para su operación.
"Sea lo que sea lo que la naturaleza tiene reservado para la humanidad, por desagradable que pueda ser, los hombres deben aceptar, que la ignorancia nunca es mejor que el conocimiento" (Enrico Fermi).
Referencias para lectores curiosos, más información en:
[1] Foro de la Industria nuclear Española: www.foronuclear.org/
[2] Westinghouse Company: www.westinghousenuclear.com/
[3] Consejo de Seguridad Nuclear (CSN): www.csn.es/
[4] Central Nuclear Almaraz Trillo: www.cnat.es/
Emma López-Alonso Conty
Doctor en Ciencia y Tecnología Nuclear
Yo quiero ser, y soy, inventor. Qué le voy a hacer, si es lo que me gusta, y además parece que se me da bien. Voy a contar mi experiencia, esperando que sirva de motivación para unos, y de guía para otros (de lo que pueden hacer, o de lo que no 😉). En realidad inventar es una actividad puramente de ingeniería: se emplea el ingenio, junto a los conocimientos científicos y técnicos, la experiencia, la observación, y el esfuerzo, para tratar de encontrar nuevas soluciones a problemas existentes. Vamos, una buena definición de lo que es Ingeniería.
De hecho, el grupo con el que desarrollo las invenciones, el Grupo de Modelado Y Simulación en Ciencia e Ingeniería de la Universidad de La Rioja, está formado por ingenieros de todo tipo y condición: ingenieros eléctricos, mecánicos, el electrónica y automática, de sistemas, de telecomunicaciones, etc., aunque a decir verdad, para esta actividad cualquier aportación puede ser buena, y no despreciaríamos la ayuda de matemáticos, físicos, o incluso de cualquier persona con titulación de letras, sin titulación de ningún tipo, y hasta de niños (nuestros hijos han llegado a aportarnos ideas muy interesantes) para colaborar en la búsqueda de soluciones, sobre todo en las labores iniciales de búsqueda de problemas y lluvia de ideas de soluciones.
¿Y en qué consiste ser inventor? Pues básicamente consiste en buscar algún problema existente, estudiar las posibles soluciones que ya existen para ese problema, y las ventajas e inconvenientes de esas soluciones, para aplicar la actividad inventiva en busca de una nueva solución que mejore lo ya existente. Muchas veces esas labores son premeditadas, y otras simplemente llega la idea para algún problema al que les has estado dando vueltas mucho tiempo anteriormente.
Si la invención es suficientemente sólida y estamos seguros de que es explotable, entonces hay que patentarla, teniendo en cuenta los gastos que ello conlleva y también que a veces buenos inventos no llegan a materializarse en el mercado. Pero si efectivamente lo que hemos inventado triunfa, tendremos prioridad sobre el invento durante 20 años en los países en los que lo hayamos patentado, y podremos o bien explotarlo nosotros o bien licenciar la patente para que la explote otro (normalmente una empresa experta en el sector). Hay quienes prefieren no hacer la patente incluso en inventos claramente explotables, básicamente por dos motivos. Unos porque prefieren compartir su invención con el resto del mundo renunciando a esa prioridad. Nosotros creemos que eso es un error, pues precisamente la prioridad es una recompensa por haber compartido el conocimiento de tu invención, y porque los beneficios pueden emplearse para desarrollar nuevas invenciones (además de para vivir, que los ingenieros somos profesionales, que aportamos nuestros conocimientos como profesión, para vivir de ello). Otros no patentan para mantener el "secreto industrial", ya que cuando se patenta algo hay que proporcionar TODA la información que haga falta para poderlo fabricar (hay que compartir plenamente la información), y pasado el tiempo de prioridad esa información la puede emplear cualquier persona.
De lo que acabo de comentar puede deducirse que una patente no consiste simplemente en tener la idea de un invento (al estilo de lo que saca de su bolsillo mágico Doraemon , sino que tenemos que decir cómo se consigue fabricar esa idea. Por poner un ejemplo (algo radical) no podemos patentar la idea de una cabina de teletransporte (la "puerta mágica de Doraemon") salvo que sepamos cómo hacer una.
A veces las invenciones son ideas muy simples (lo que no impide que puedan ser tremendamente eficaces), en cuyo caso exponer cómo se fabrica es muy sencillo o incluso evidente, y otras veces son sistemas altamente complejos que requieren una presentación técnica de gran nivel de dificultad.
Como ejemplo de invención simple podemos poner un invento español bien conocido, la fregona, aunque no sólo consistió en ponerle un palo al trapo de limpiar sino que además incorporaba el sistema de "estrujarlo" para extraer el agua en el caldero. Otro invento, también de aportación española, es el del caramelo con palo, lo que hoy en día conocemos por la marca que lo comercializa (chupa-chups), y que en realidad lo que hizo fue comercializar muy bien un producto, que no pudo patentar, pero sí pudo hacerse con los derechos de las patentes que existían y estaban en vigor, pues antes de su intento de patente existían otras (como la patente nº 70454:¨Un sistema de confección de caramelos de diversos tamaños y formas provistos de una espiga o mango, que penetrando parcialmente en la masa, queda sólidamente unido a ella, pudiéndose utilizar el extremo libre como cogedor). También como ejemplo de patente simple que me ha fascinado por su combinación de simplicidad y utilidad, es la cisterna de inodoros que acabo de ver en mi último viaje a Japón: una cisterna se llena después de cada uso del inodoro, con agua potable, que se va a desperdiciar, y posteriormente nos lavamos las manos en el lavabo con agua potable que también se pierde con ese uso; lo que hace esta invención es incorporar un lavabo sobre la cisterna, con un grifo que se activa al vaciarse la cisterna para llenarla de nuevo, como haría una cisterna normal, pero en este caso se llena desde un grifo por encima que permite lavarnos las manos con el agua con la que se llenará la cisterna y que se empleará la siguiente vez que "tiremos de la cadena". Sistema tremendamente útil y sencillo, por el que me alegro que alguien haya podido conseguir una buena recompensa, bien merecida.
Como ejemplos de invenciones complejas, cuya descripción incluye complicadas conexiones de elementos y dispositivos mecánicos, eléctricos y electrónicos, pondré alguna de las nuestras, como "Interruptor automático de protección contra contactos directos", o "Central Eléctrica de baja tensión energizada con descargas atmosféricas", o "Bicicleta eléctrica regenerativa", entre las muchas (ya acercándonos a 100) que pueden verse en la OEPM. En realidad, si queréis ver las patentes que he realizado, o las que ha realizado cualquier persona en España, o las que existen en nuestro país sobre algún tema, basta con que vayáis a la Web de la Oficina Española de Patentes y Marcas, y entréis dentro del apartado de bases de datos de invenciones en la base Invenes.

Pero para motivaros en esta apasionante dedicación de las invenciones, voy a mostraros las 2 patentes más mediáticas hasta el momento de las desarrolladas hasta ahora.
La primera de ellas se denomina "Dispositivo avisador antirrobo del cableado eléctrico de un alumbrado exterior", ha sido realizado para el Ayuntamiento de Logroño, y consiste en un sistema que detecta al instante y avisa del robo de cable de alumbrado, uno de los mayores problemas de los ayuntamientos actualmente en todo el país.
La segunda se denomina "Dispositivo automático para inflado de neumáticos" y junto con su patente complementaria, denominada "Procedimiento automático para inflado de neumáticos", fueron premiadas con la edición 2017 del Premio Ponle Freno AXA a la Innovación, lo que ha constituido para nosotros como inventores un grandísimo honor, especialmente en el momento de entrega del Premio, en el Palacio del Senado, por el prestigioso presentados de Televisión Matías Prats y en presencia de varios Senadores, Ministros y Directores Generales.

El invento consiste en un dispositivo (como un tubo toroidal) en el interior del neumático, cargado con aire a alta presión, que permite rellenar de aire el neumático si es necesario, bien porque se haya pinchado o bien porque sea más conveniente para la conducción, y por eso también puede reducirse la presión del neumático para mejorar la conducción dependiendo de las características de la carretera, sabiendo que se podrá volver a inflar al instante cuando se necesite.

Juan Carlos Sáenz-Díez Muro
Doctor Ingeniero Industrial
Universidad de la Rioja
No ha pasado mucho tiempo desde el momento en el que tuve que tomar una de las decisiones más trascendentales de mi vida: Qué carrera estudiar. O, al menos, eso era lo que me parecía en aquel momento. La cuestión era permanente: ¿Matemáticas o Física? Disfrutaba muchísimo aprendiendo sobre ambas y soñaba con poder dedicar mi vida a estudiar algo que las combinase, pero en la época pre-doble grado en matemáticas y física había que elegir una para comenzar. Y sin una idea clara de a qué me dedicaría tras la época universitaria, se me antojaba que una decisión equivocada en este momento condicionaría el resto de mi vida laboral.
¡Nada más lejos de la realidad! Finalmente, elegí estudiar matemáticas y tomar algunos cursos de física, con la finalidad de dedicarme a la investigación en algún campo de intersección entre ambas, pero por el camino he descubierto que a la misma situación en la que me encuentro actualmente podría haber llegado de muchas otras maneras. Y también que, aunque durante la época de secundaria y carrera parezca en numerosas ocasiones que uno se puede dedicar a las matemáticas o a la física, pero no a las dos, la investigación en los abundantes puntos en los que ambas se cruzan es de lo más interesante que se puede encontrar.
En este capítulo, voy a hablar de un campo que se incluye dentro de la Matemática Física y se llama Información Cuántica. De hecho, es un campo que se encuentra en la intersección entre las matemáticas, la física y la ciencia de la computación y en el que se trabaja tanto en la parte académica como en numerosas empresas relacionadas con la tecnología informática. Tiene como principal finalidad el desarrollo de un ordenador cuántico, con todo lo que ello conlleva.
¿Qué es la Teoría de la Información Cuántica?
Vivimos en un mundo en el que el desarrollo de las tecnologías está a la orden del día, y en el que los medios de comunicación juegan un papel fundamental. Sin embargo, raramente conocemos cómo funciona la transmisión de información. Aunque sí sabemos que, para enviar una fotografía, audio o vídeo, se empleará una cantidad diferente de bits dependiendo de la complejidad de los archivos. En general, la teoría que describe los procesos de transmisión y procesamiento de la información es la Teoría de la Información, cuyas bases fueron establecidas por Claude Shannon hace más de medio siglo.
A partir de los primeros trabajos de Shannon, la teoría fue creciendo conforme lo hacía la necesidad de comunicación en la sociedad. Uno de los aspectos más positivos de dicha teoría es que se puede explicar a partir de una base muy sencilla, a la vez que su desarrollo alcanza una gran abstracción matemática. Para ello, se introdujo el concepto de bit. Un bit es un dígito del sistema de numeración binario, es decir, sólo puede tomar el valor 0 o el 1 (podemos imaginarlo como una bombilla que se encuentra apagada o encendida). Para codificar información en un dispositivo se utilizan secuencias de bits, en las que la posición de cada bit es determinante. Cuanto mayor es la información que se quiere transmitir, mayor es el número de bits necesarios, y, por tanto, mayor debe ser el tamaño del soporte del que se disponga y de las memorias en las que se almacenen. El proceso de miniaturización tecnológica que comenzó a desarrollarse entonces fue de los más importantes avances tecnológicos de la época, dado que también proporcionó un aumento en la velocidad de transmisión de la información.
Sin embargo, a principios de los 80 se planteó una situación problemática: de continuar reduciendo el tamaño de los dispositivos mencionados anteriormente, en algún momento se llegaría a una escala microscópica, ¡en la que las leyes de Newton no pueden predecir los fenómenos que se producen! De este hecho precisamente surgieron a finales del siglo XIX una serie de experimentos que darían lugar después a la Física Cuántica. Por tanto, la computación digital tradicional no tardaría en llegar a su límite, puesto que ya se habían alcanzado escalas nanométricas. Surgió entonces la necesidad de trabajar en nuevos campos de la física para desarrollar nuevas tecnologías, y ahí la Información Cuántica entró en escena.
La idea en la que se fundamenta la computación cuántica es la siguiente. Mientras que en la computación clásica un bit sólo puede tomar dos valores, 0 ó 1, en la computación cuántica intervienen las leyes de la mecánica cuántica y, puesto que una partícula puede estar en un estado de superposición, se puede encontrar en el estado 0, en el 1, ¡o en el 0 y el 1 a la vez! Esto permite que se puedan realizar varias operaciones a la vez, según el número de qubits, lo que conlleva una gran mejora respecto al caso clásico. Lo podemos ver en el siguiente ejemplo: Si tenemos un vector de 3 bits, la partícula puede tomar 8 valores distintos, pero solo uno a la vez. Sin embargo, si tenemos un vector de 3 qubits, se pueden tomar los 8 valores distintos a la vez, de forma paralela. Por tanto, el número de operaciones permitidas por una secuencia de qubits es exponencial con el número de qubits.
Este hecho hace que diseñar un ordenador cuya unidad fundamental de información sea el qubit, el llamado ordenador cuántico, sea un problema muy estudiado y de gran interés en todo el mundo actualmente. Se cree que en los dispositivos a partir de 50 qubits ya se empezarán a obtener resultados interesantes, ya que la cantidad de operaciones a las que darán lugar en paralelo será de 250, es decir, ¡un número de 15 cifras! Y con un ordenador de 300 qubits, se podrán realizar en paralelo tantas operaciones como partículas hay en todo el universo. Esto permitirá resolver problemas que con los computadores actuales no se pueden resolver, aunque provocará que los sistemas de cifrado actuales dejen de ser útiles, puesto que se podrán descifrar de forma rápida y sencilla, lo que está propiciando el desarrollo de un nuevo campo llamado criptografía cuántica.
Por el momento, al ordenador cuántico todavía le queda bastante para poder ser comercial. A principios de 2018, los prototipos más potentes que se han presentado tienen alrededor de 50 qubits: Google ha presentado uno de 49 qubits, IBM uno de 50 y el Moscow Institute of Physics and Technology, uno de 51.

(a) Prototipo de 5 qubits; (b) Prototipo de 17 qubits; (c) Prototipo de 50 qubits; (d) Refrigerador de IBM
Sin embargo, los qubits, a diferencia de los bits, son muy sensibles y cualquier interacción que tengan con el entorno puede modificar completamente el cálculo, por lo que es necesario mejorar el aislamiento de este tipo de computadoras, el que es probablemente el mayor problema con el que se encuentran este tipo de empresas a la hora de intentar realizar prototipos con un mayor número de qubits. En la siguiente tabla recogemos una serie de fotografías sobre distintos prototipos presentados por IBM.
¿Cómo puede investigar un/a matemático/a en Información Cuántica?
Una pregunta de carácter tan general como la anterior, difícilmente admite una respuesta global. No me planteo buscarla en esta sección; mi intención es simplemente contar qué intento aportar yo, como matemática, a este campo.
Dentro del proceso de creación de un ordenador cuántico, es esencial diseñar dispositivos en los que se pueda almacenar la enorme cantidad de información que estos ordenadores manejan. Puesto que se espera que los ordenadores cuánticos aumenten exponencialmente la información con la que trabajan los clásicos, de igual manera deben aumentar su capacidad los dispositivos en los que se almacene dicha información, también llamados memorias cuánticas. Y a pesar de que, por el momento, no hay una opinión unánime sobre cómo debe ser exactamente una memoria cuántica, hace unos años se realizaron unos estudios, que se enmarcaron en lo que se conoce como ingeniería cuántica, en los que se mostró que unos buenos candidatos a memorias cuánticas son los llamados sistemas cuánticos de muchos cuerpos abiertos que verifican la propiedad de mezclado rápido.
Los sistemas cuánticos de muchos cuerpos abiertos están formados por una gran cantidad de partículas que interaccionan entre sí, rodeadas por un entorno que las influencia de forma no despreciable. Estos sistemas también se pueden ver como disipativos, en los que la energía se disipa hasta alcanzar un equilibrio térmico con el entorno (como cuando se deja un plato de comida caliente en una habitación y tras un tiempo éste se ha enfriado).
Los sistemas disipativos con los que trabajamos siempre convergen a un estado de equilibrio, ¡aunque puede que esto suceda en un tiempo infinito! Sin embargo, no nos interesa estudiar el tiempo que tardan en converger, sino la velocidad. Si esta velocidad es suficientemente alta, se dice que hay mezclado rápido, y, por tanto, el material con el que se está trabajando es un buen candidato a memoria cuántica.
Consecuentemente, dado un sistema cuántico de muchos cuerpos abierto, el problema de estudiar si tiene la propiedad de mezclado rápido es un problema extremadamente útil, a la par que interesante. Y para atacarlo, son necesarios amplios conocimientos matemáticos.
Conclusión
La Información Cuántica es uno de los campos más transversales que ha surgido en los últimos años, puesto que se encuentra en la intersección entre las matemáticas, la física y las ciencias de la computación. Constituye un mundo de interés no sólo en la parte académica, sino que trata de un tema ampliamente estudiado por las más importantes empresas del planeta relacionadas con la computación y el desarrollo de la tecnología, puesto que su principal objetivo, la obtención del ordenador cuántico, supondrá, probablemente, una de las grandes revoluciones tecnológicas del siglo XXI. Sin embargo, el trabajo acaba de empezar; aún queda mucho hasta llegar al ansiado computador cuántico comercial. Mientras tanto, cada día nuevas personas a lo largo del mundo deciden aportar su granito de arena para que ello suceda.
¡Tú puedes ser el siguiente!
Referencias:
-. Introducción a la información cuántica: http://www.fgcsic.es/lychnos/es_es/articulos/informacion_cuantica
-. Desarrollo de la computación cuántica en el tiempo: https://es.wikipedia.org/wiki/Computación_cuántica
-. Estado de la computación cuántica a principios de 2018:
-. Fotografías: IBM.
Ángela Capel Cuevas
Estudiante de doctorado en Matemáticas
Instituto de Ciencias Matemáticas (CSIC-UAM-UC3M-UCM)
Saludo desde estas líneas a las personas que desarrollarán ciencia y tecnología en los próximos años y lo hago firmando como matemática industrial. Si tengo que concretar unas coordenadas temporales para identificar el inicio de mi vocación respondo con un depende de gallega que trataré de explicar.

Fig. 1. Visita al IES As Lagoas Mayo 2017
Mi gusto por entender y la seguridad que me daban las Matemáticas se remonta a los comienzos de mi formación. En el Instituto, entonces lo iniciábamos con 14 años en equivalencia con tercero de la ESO de ahora, tenía claro que me gustaba resolver problemas. Esta competencia se desarrollaba sobre todo en Matemáticas, pero luego este reto reaparece en Física y en Química. La foto que acompaña a este texto es con mis profesores de Física, y Química, Arias y Boullón, y mi profesora de Matemáticas, Lourdes, cuando volví al instituto, 33 años después de terminar, para participar en las Jornadas Matemáticas. Creo que el salir con los ojos cerrados es un retrato del sueño que supuso volver a mi casa académica, para contar lo que gracias a sus impulsos pude hacer. Les llevaba un ejemplo de aplicaciones a la red de gas, al agua y también a la parte de la Biología al hablarles del flujo en sangre, y mi profesora de Biología también estaba presente.
Seguro que esta experiencia la vivirá alguna alumna, hoy de instituto, que lea estas líneas. Confesé en mi intervención que dar esa charla era una deuda y al mismo tiempo una refutación que tenía pendiente con mi yo de 18 años. Hoy en día los centros de enseñanzas medias son muy dinámicos organizando jornadas de este tipo, pero hace 33 no había muchas conferencias y recordaba que en una ocasión que no conocíamos el tema de la conferencia, me aventuré a decir que de lo que estaba claro es que no sería era de Matemáticas. ¿Cómo se iba a hablar una hora de mates? Pensaba yo hace 33 años, sin hacer ejercicios o poner ejemplos. ¡Ese no podía ser el tema! No lo era en esa ocasión, pero tenía que enseñarle a María Elena, que sí se podía hablar de Matemáticas.
Fue una experiencia entrañable, me reencontré con profesores y alguna compañera de facultad y volví con apuntes sobre un matemático gallego al que admiro, Domingo Fontán, que quiero compartir con las lectoras y los lectores, para con un ejemplo gallego histórico ilustrarles la Matemática Industrial.
Domingo Fontán Rodríguez (Portas, 1788 - Cuntis, 1866) fue un visionario. La suya fue una labor grandiosa y su compromiso con la ciencia, inquebrantable. Se formó en la Universidad de Santiago de Compostela (USC) en muchas disciplinas hace unos doscientos años, y entre ellas estaban las matemáticas. Fue discípulo del matemático José Rodríguez González, otro referente de la matemática gallega, que participó en la medición del meridiano de Greenwich. Con este maestro y mentor de referencia, Fontán decide asumir el reto de realizar la "Carta geométrica de Galicia". Una gran aventura matemática con la impronta de compromiso social de comunicar Galicia. Él tenía claro que el desarrollo de nuestra tierra pasaba por establecer una red de comunicaciones y para definirla era necesario conocer con precisión la topografía del territorio. Este fue el planteamiento que se hizo cuando en 1817 asumió el reto. La solución, un regalo científico y tecnológico, es la realidad de la Carta geométrica.

Fig. 2. Con el Fontán de Otero Pedrayo en Trasalva (Ourense)
El trabajo concluido en 1834 se presentó oficialmente a la Reina María Cristina de Borbón-Dos Sicilias, y la impresión de la misma se hizo en 1845 en París. Para ello recorrió durante 17 años Galicia en burro, realizando una triangulación del territorio y midiendo en cada vértice la presión atmosférica a las mismas horas que su hermano lo hacía en Noya, para posteriormente obtener la altura. Para identificar correctamente la triangulación sin fronteras, que Fontán calculó para Galicia, necesitó medir no solo los ángulos de cada triángulo, le hacía falta calcular al menos un lado de un triángulo, lo que hizo midiendo con varas. Para validar los cálculos y filtrar errores decidió calcular dos lados y verificó la precisión de las medidas. Para valorar el reto logrado debemos de ser conscientes que lo inició hace doscientos años.
Seguro que ya están preguntándose si finalmente el trazado de los ferrocarriles y las carreteras gallegas tienen ADN del Fontán, que es así como se reseña este mapa en textos de los grandes literatos gallegos como Otero Pedrayo, que creció imaginando viajes por Galicia en el Fontán que tenía en casa, con el que me retraté en la Fig. 2. ¡La respuesta es afirmativa!
Si ahora preguntase como resumir en dos palabras la conexión entre objetivo formulado y la metodología científica empleada por Domingo Fontán, seguro que Matemática Industrial puede ser un buen binomio de respuesta.
Si este fue un reto logrado hace doscientos años, no seré yo quien ponga límites a los de las personas que hoy sienten admiración conociendo la figura de este ilustre matemático cuyos restos reposan hoy a los pies de los de Rosalía de Castro. Sois vosotras y vosotros, si me permitís la confianza de colegas en algún instante temporal, quienes tenéis que soñarlos e imaginarnos.
En este texto juego a adivinar mi profesión en el futuro intersecando el tiempo en 33 años y me aventuro desde el pasado a decir lo que sé que seré hoy.
Cuando tenía las mismas dudas, mis referentes eran mis profesores del instituto. Primero pensé en hacer Física, tener como profesor al Señor Arias, generó mi primera vocación. Pero cuando aparecieron las dudas, el que actuó de mentor en el camino de la decisión, fue Alfonso Amorín, mi profesor de Matemáticas en COU, actualmente presidente de la empresa gallega EDISA. Por aquel entonces, año 1984 no se conocía en binomio Matemática Industrial, pero sin el término, yo confieso que era con lo que soñaba: hermanar la física y las matemáticas para resolver problemas, y hoy puedo compartir que es lo que hago. En diferentes escritos he agradecido a todos estos docentes su capacidad para enseñarnos las disciplinas que los motivaron y que hicieron nacer nuestras vocaciones, por sus lecciones y por atendernos también en los caminos de las dudas.
Si sigo despertando preguntas, y hay lectores que me acompañan en esta parte del texto, seguro que quieren saber qué hice, cuáles son mis granitos de arena de hermanamiento de las matemáticas con otras disciplinas para resolver problemas.
Seguí el camino de la investigación gracias a encontrarme a uno de los referentes de la Matemática Industrial, el profesor Alfredo Bermúdez del Departamento de Matemática Aplicada de la USC. Él me brindó poder desarrollar, con la beca de colaboración del último año de carrera, un proyecto que sería mi tesina de licenciatura para resolver las ecuaciones de las aguas someras con la metodología de volúmenes finitos.

Fig. 3. Cálculo de la propagación de una onda de marea en la ría de Pontevedra.
La motivación de estos problemas estaba en un proyecto con la Xunta de Galicia para el estudio de las corrientes en las rías gallegas. Trabajar con el Prof. Bermúdez es uno de los grandes regalos que siempre agradeceré a mi universidad, la USC. El tema, al no existir en el año 1989 un software que permitiese hacer los cálculos, nos llevó a una tesis doctoral, de la que es director, para desarrollar métodos numéricos que calculasen correctamente las corrientes cuando el fondo no es plano, esto es, respetando la batimetría, la topografía del fondo de las rías.
Aprendimos como hacerlo y lo compartimos con la comunidad científica en forma de publicaciones. Además, forma parte de un software, TURBILLON registrado en 2005, que se enriqueció con el trabajo desarrollado por un compañero de la Universidade de A Coruña (UDC), Luis Cea, con el que aprendí mucho al actuar de codirectora de su tesis doctoral junto con el también profesor de esa universidad, Jerónimo Puertas. En este trabajo aportamos la implementación de modelos de turbulencia bidimensionales y resolvimos problemas de escalas de peces, ver Fig. 4. Gracias a la formación de los profesores de la UDC, son Ingenieros de Caminos, pudimos realizar validaciones experimentales. Es estos problemas son los profesionales de la Bilogía los que nos indican los caudales y los calados óptimos para el desarrollo de las escalas atendiendo a las especies que viven en los ríos. Medir errores y aprender de ellos para cuantificar en qué medida nuestros modelos representan la realidad es hacer lo que soñaba, cuando no sabía poner nombre a lo que sería.

Fig. 4. Simulación en una escala de peces en la que se representa el módulo de la velocidad calculado.
Esta conexión con la UDC nos llevó a colaborar con la Universidad Politécnica de Cataluña y pasar de un software registrado, al proyecto Aula Iber y al software libre del mismo nombre, Iber, con una gran proyección nacional e internacional, con el que se están resolviendo muchas regiones del mundo.
En este camino seguimos aprendiendo de las matemáticas y con las matemáticas para aplicarlas a problemas reales. Estos estudios nos permitieron trabajar en un contrato gestionado por el Instituto Tecnológico de Matemática Industrial (ITMATI) con Endesa Generación S.A. Se trataba de hacer una simulación numérica del sistema hidrológico del Eume en las inmediaciones del Lago minero para determinar el deslinde del lago y el dominio público hidráulico. El compañero de trabajo en este contrato fue Pedro Fontán, y para el mismo empleamos la metodología desarrollada en su trabajo fin de máster, del Máster en Ingeniería Matemática, que luego se transformó en el Máster en Matemática Industrial (www.m2i.es).
Para finalizar me gustaría compartir, que además de aplicaciones variadas en el contexto de la resolución de las ecuaciones de las aguas someras, con las que comencé a tener contacto gracias a la beca de colaboración, las matemáticas permiten aplicar las mismas metodologías a problemas aparentemente muy diferentes.
Comenzaba diciendo que en mi visita al instituto presente problemas de simulación en redes de gas, el trabajo forma parte de un contrato liderado por el Prof. Bermúdez con la empresa Reganosa y dio lugar al software "GANESO: Simulación y Optimización de Redes de Gas". En el código de este software, en la parte transitoria, está implementado el método de volúmenes finitos en el que también desarrollamos contribuciones que hemos publicado y que siguen las metodologías que empleamos para resolver los modelos de corrientes en las rías y en las escalas de peces. De nuevo tener en cuenta la topografía, los tubos de la red de gas van enterrados, la que Fontán calculó en la Carta Geométrica, es un tema que nos ocupa a las personas que nos dedicamos a la Matemática Industrial hoy.
Gracias desde estas líneas a todas las personas con las que comparto autoría de trabajos y proyectos, por todo lo aprendido y compartido en el camino de la Matemática Industrial.
Gracias a ti, lectora o lector, por llegar al final por hoy de esta historia. ¡Te deseo que pronto seas tú lo que quieras ser!
M. Elena Vázquez Cendón
Doctora en Matemáticas, Profesora Titular de Matemática Aplicada, Universidade de Santiago de Compostela
Quiero empezar este capítulo, aclarando que hace diez años no tenía idea de que terminaría aplicando las matemáticas a la biología y en particular a la pesca.
Las matemáticas ocuparon siempre un lugar importante en mi vida, en el colegio me gustaban y se me daban bien, había una cierta alegría en la resolución de problemas y en esos instantes cuando comprendía de verdad algún concepto, además lo mágico que hay en las matemáticas es que cuando entiendes un concepto, se abre una estructura completa ante ti y el significado de muchos conceptos más se abren, como abrir una caja que contiene muchos compartimentos.
Recuerdo cuando tenía 15 años y estaba en plena crisis adolescente, me encontraba en estado de desasosiego y empecé a resolver identidades trigonométricas, una mezcla entre lógica y trigonometría, y la calma llegó y el tiempo pasó sin que lo notara.
Cuando encuentras algo que te lleva a la calma y que a su vez despierta en ti mucha curiosidad, te das cuenta que has encontrado un tesoro. Buscando saber más de ese tesoro decidí estudiar matemáticas en la mejor Universidad de mi país de nacimiento, la Universidad Nacional de Colombia y es allí donde tengo dos revelaciones que cambiaron la visión que tenía hasta entonces. La primera, que las matemáticas que me habían enseñado en el colegio, eran matemáticas antiguas, que llevaban gestándose desde antes del 400 a.c (Pitágoras y otros pensadores importantes nacieron por esa época), es decir que mis profesores habían intentado enseñarme los descubrimientos hechos durante aproximadamente 2000 años en los 10 años que estuve en el colegio. Normal que a veces uno se sintiera atosigado y no entendiera para que servían tantas cosas, a veces no había tiempo para poner tanto conocimiento en el contexto adecuado. Sin embargo, los dos primeros años de la carrera también estaban dedicados a las matemáticas antiguas, aunque ya abarcaban un periodo más reciente, se podría decir que de 1800 en adelante. La segunda revelación, que tiene que ver con la primera, es que para estudiar matemáticas no hay que ser muy inteligente, hay que dedicarle tiempo, ser muy constante y hay que tener paciencia, porque entender todo lo que se ha hecho en los últimos 2000 años requiere trabajo, y como decía un querido profesor de la universidad, las matemáticas más que con la cabeza se hacen con el culo, refiriéndose a la cantidad de horas que pasaba uno sentado frente al papel intentando resolver problemas varios.
Yo decidí dedicarme a una rama de esas matemáticas antiguas que se remonta al siglo XVIII cuando Thomas Robert Malthus empezó a encontrar patrones matemáticos analizando varias poblaciones humanas, estos estudios demográficos fueron la base de lo que hoy se conoce como ciencia de pesquerías. Esta rama de la ciencia gira en torno a la resolución de la siguiente pregunta: ¿Cuántos peces hay en el mar?
La necesidad de resolver este interrogante radica en que la pesca es muy importante para nosotros desde el punto de vista ecológico y económico: hace parte de la biodiversidad siendo un eslabón de la cadena alimenticia y miles de familias alrededor del mundo logran subsistir gracias al gran número de trabajos que genera la pesca. A principios del siglo XX algunos científicos postularon que era imposible que los peces se acabaran, en una época donde no se explotaba el mar de la forma en que se hace ahora, ya en esta época sabemos que eso no es cierto porque lamentablemente han colapsado grandes pesquerías (como el Bacalao en Terranova o la anchoveta en Perú). Por lo tanto, si sabemos cuántos peces hay, podemos encontrar un límite que permita que los peces se reproduzcan con éxito pero que a su vez la pesca sea rentable económicamente.
Sin embargo es imposible responder a esta pregunta de forma exacta, los peces se mueven constantemente y no disponemos de un sistema de monitorización en una extensión tan grande como la que ocupa el mar, lo único que podemos hacer es aproximar y es aquí donde las matemáticas empiezan a ser útiles. La cantidad de peces en un área se aproxima usando modelos matemáticos.

Fig. 1. Diagrama del ciclo de vida de la anchoa (boquerón) en el Golfo de Cádiz incluyendo los factores ambientales que afectan las diferentes etapas. Cortesía de Integration and Application Network, University of Maryland Center for Environmental Science (ian.umces.edu/symbols/). Tomada de [1].
Para esos modelos se necesitan datos, por un lado los pescadores están obligados a registrar todo lo que pescan y esta es una de las principales fuentes de información de las que disponemos, pero por otro lado los organismos de investigación realizan periódicamente campañas oceanográficas en las cuales un barco con una ecosonda traza una ruta delimitando una zona determinada, y este barco a su vez pesca pequeñas cantidades para hacerse una idea del tamaño, peso, madurez y edad de los peces que se ven con la ecosonda. Toda la información proveniente de las capturas y de las campañas es el alimento de los modelos matemáticos.
En esos datos se buscan patrones que permitan responder preguntas intermedias como ¿Cuántos huevos pone una hembra?, ¿Cómo es el crecimiento de la población? ¿Hay otros factores en el ecosistema que afecten la supervivencia de los peces?
En el caso de la anchoa (conocido también como boquerón) en el Golfo de Cádiz, estos modelos han permitido encontrar conexiones entre los fuertes vientos de levante y la mortalidad de los peces cuando estos aún son muy pequeños: el viento los arrastra con fuerza hacia grandes corrientes donde su supervivencia es muy difícil. También sabemos que hacen la puesta de huevos cuando las temperaturas son altas y que lo hacen cerca de la desembocadura del río Guadalquivir, que el agua dulce del río hace que esa zona sea muy rica en nutrientes favoreciendo su desarrollo y que si al contrario viene poca agua dulce del río (por ejemplo cuando llueve muy poco) su mortalidad es mayor (Fig. 1).
Conociendo todas estas variables y los procesos involucrados podemos estimar si el año siguiente habrán muchos o pocos boquerones y así los científicos cada año damos una recomendación de cuánto se puede pescar de forma sostenible.
A modo de conclusión
La importancia de los peces dentro del ecosistema y la de la pesca como fuente de alimentación y de generación de empleo ha incentivado el desarrollo de modelos matemáticos que permiten sintetizar el ciclo de vida de los peces incluyendo la influencia del ecosistema y el efecto de la pesca. En estos modelos se aprecia cómo interactúan la biología, la física, la oceanografía, la estadística, las matemáticas e incluso hasta la economía y la política. La ciencia pesquera es un campo interdisciplinar donde la comunicación fluida entre las partes favorece la buena gestión.

Conoce, comparte, divulga, participa.
Yo que venía de un mundo de números he encontrado en esta aplicación la forma de convertir muchas ecuaciones en un beneficio tangible para la sociedad y el ecosistema.
Referencias:
[1] Margarita María Rincón, John D. Mumford, Polina Levontin, Adrian W. Leach, Javier Ruiz; The economic value of environmental data: a notional insurances cheme for the European anchovy, ICES Journal of Marine Science, Volume 73, Issue 4, 1 March 2016, Pages 1033–1041, https://doi.org/10.1093/icesjms/fsv268
Margarita María Rincón Hidalgo
Twitter: Margarita_RH
Doctora en Física y Matemáticas
Investigadora Postdoctoral en el Instituto de Ciencias Marinas de Andalucía (ICMAN-CSIC)
Desde que ser estudiante es acudir a una Escuela Infantil para aprender cantando y jugando, el oficio de escolar se va complicando a medida que avanzamos en los diferentes estadios del sistema educativo.

Poco a poco empiezan a hacer aparición libros de texto, cuadernos de apuntes, hojas de ejercicios, fichas de ordenador o en internet, calendarios, horarios, trabajos en grupo, proyectos, exámenes, reválidas y selectividades,...
Pero cuando ser estudiante empieza a parecerse definitivamente más a una profesión que a una ocupación formativa es cuando llega la hora de hacer elecciones importantes, lo cual necesariamente genera tensión y ansiedad. Elegir entre varias optativas o especialidades de Secundaria, entre Bachillerato o Formación Profesional (FP) o, llegado el momento, elegir la carrera, son decisiones relevantes que definirán en gran medida el bagaje cultural, formativo y metodológico con el que abordaremos el resto de nuestra vida profesional, al menos en sus primeros pasos.
Hay en todas esas elecciones un cierto grado de irreversibilidad que, afortunadamente, no es completa, por supuesto, pero sí importante. En efecto, podemos elegir una carrera y, al acabarla, hacer otra o cambiar a medio camino. Podemos pasar de un Bachillerato a otro, o del Bachillerato a la FP o viceversa. Pero cada uno de esos cambios supone invertir al menos un curso académico más y, aunque a veces es conveniente, recomendable y necesario hacerlo, siempre se genera una cierta frustración y tensión en uno mismo y su entorno.
Conviene pues, desdramatizando la coyuntura, elegir bien. Y hay, diría, dos tipos de criterios: uno es el de las salidas profesionales y el otro, el del gusto y el interés personal por las diferentes materias y opciones académicas.
Todos compartimos experiencias semejantes. Yo, en 1979, al elegir la carrera, y aunque eran tiempos de crisis económica en el entorno, animado por mi familia, me decanté por dar prioridad al segundo criterio, el de mi propia pasión por las Matemáticas.
En aquel momento la carrera, que se denominaba de "Exactas", se percibía como casi sin salida alguna más allá que la docencia en el Bachillerato puesto que, en particular, las oportunidades de desarrollar una carrera profesional en la Universidad eran escasísimas y eran pocos los ámbitos de actividad económica en los que un matemático era considerado potencialmente útil.
Pero lo que desde pequeño me gustaba eran las Matemáticas. Había opciones afines como la Ingeniería, que con contenidos matemáticos importantes, gozaba de más prestigio social y, sin duda alguna, ofrecía un abanico más amplio de salidas profesionales. Estaba también la opción de estudiar Economía, con una vinculación más directa con el tejido productivo y el mundo de las finanzas, de tanta tradición en nuestro país.
Pero llegado el instante decisivo me decanté por seguir mi instinto y apostar por lo que realmente me gustaba, asumiendo el riesgo de entrar en un túnel académico que conduciría a un destino profesional incierto.
Hasta hoy no me he arrepentido.
Es importante, en efecto, elegir la carrera en función de la pasión, del impulso y gusto personal y estudiar con alegría, ilusión y dedicación, lo que realmente a uno le gusta.
Hoy vivimos un momento dulce para las Matemáticas a nivel mundial. En la que podríamos denominar la década de los datos, el diploma de matemático es uno de los más codiciados en el mercado laboral. Así lo indican todos los rankings y clasificaciones de los países más avanzados: Informáticos, Estadísticos y Matemáticos están entre los diplomas más demandados.
Por tanto, hoy hay más razones que nunca para elegir una formación en Matemáticas. Pero, con independencia de estas circunstancias, animo a todos los jóvenes con un gusto genuino por esta disciplina a elegir la carrera, sin dudarlo.
Al fin y al cabo, como decía Galileo, para los humanos, el universo está escrito en el apasionante lenguaje de las Matemáticas que son a su vez hoy, más que nunca, la llave que abre las puertas a todo un universo de oportunidades profesionales.
Como es bien sabido, las Matemáticas se caracterizan por ser a la vez tan amadas por unos pocos como aborrecidas por muchos otros. Por tanto una gran mayoría de los estudiantes, llegado el momento de elegir, descartarán las Matemáticas. Razón añadida para que quienes realmente disfrutan con ellas alimenten esa pasión apostando por la disciplina.

Hay hoy en España, un buen número de Universidades Públicas que ofertan la Licenciatura de Matemáticas. En algunas de ellas, además de ofertarse en español y, cada vez más, en inglés, los estudios pueden también ser cursados en las demás lenguas oficiales del Estado. Además, tanto en las instituciones públicas como en las privadas, son cada vez más frecuentes los estudios de Máster y Títulos Propios con un fuerte contenido matemático.
Aunque lo más habitual sigue siendo que los estudiantes opten por estudiar en la Universidad más próxima, es cada vez más frecuente también que los jóvenes elijan otros campus a la búsqueda de ofertas diferenciadas. Es el caso por ejemplo del Doble Grado en "Matemáticas e Informática" de la Universidad Autónoma de Madrid o el de "Matemáticas y Física" de la Universidad Complutense. En ellos los estudiantes adquieren competencias añadidas que complementan de manera significativa la formación matemática tanto de cara a continuar con una carrera académica como con vistas a la inserción en el mercado laboral.
También son cada vez más los que se animan a intentar estudiar en los campus europeos más competitivos, a la vez que el programa Erasmus ofrece la posibilidad de una experiencia formativa complementaria en alguna universidad europea, siempre recomendable, para aquellos que decidan estudiar en España.
Nunca como hasta ahora estudiar Matemáticas había ofrecido un abanico tan amplio de opciones a la hora de hacerlo. Tampoco nunca el diploma había estado tan cotizado.

ENIAC, Crédito: De Desconocido - U.S. Army Photo, Dominio público,
Y es que, a medida que nuestra sociedad avanza y se hace más compleja, las Matemáticas se van haciendo más necesarias. En las últimas décadas el mundo de las Finanzas, de las Ciencias Médicas y de los Datos, entre otros, han ido experimentando revoluciones internas que han venido siempre acompañadas del desarrollo y uso de herramientas matemáticas más sofisticadas. Ese proceso de proliferación de los ámbitos en los que usan y necesitan de las Matemáticas, que se acentúa progresivamente, hoy se percibe con claridad también en el ámbito de las Ciencias Sociales.
Basta mirar cincuenta años atrás para ver cómo, a pesar de las calamidades que nos acechan aún en el día a día y de las que tenemos información en tiempo real gracias a los medios de comunicación en un mundo global, en forma de catástrofes naturales, guerras y atentados, el planeta ha evolucionado en promedio de manera muy positiva habiendo recortado la mortalidad infantil, el analfabetismo y la pobreza extrema a la vez que se prolongaba la esperanza de vida. La Ciencia en general y las Matemáticas en particular han jugado un papel decisivo en ese avance, digno de elogio.

Estudiar Matemáticas hoy es, más que nunca, una excelente inversión de cara a un futuro que es imposible predecir pero que, sin duda, será próspero y que estará lleno de avances científicos que afectarán a nuestro modo de vivir de manera hoy imprevisible pero que, con certeza, seguirá estando escrito en lenguaje matemático.
Enrique Zuazua
Doctor en Matemáticas
Catedrático de DeustoTech-Bilbao y la Universidad Autónoma de Madrid
¿Cuándo decidí ser matemático? Creo que tendría unos quince años cuando decidí estudiar matemáticas, pero, pese a la influencia de mi profesor de matemáticas en aquella época, nada me hubiese hecho pensar antes que sería matemático. Quizás físico o químico, probablemente arquitecto o ingeniero, como deseaba mi padre, pero no matemático. Sin embargo, ahora sé que de algún modo estaba destinado a serlo. Lo he explicado en un corto texto dedicado a mi padre y a sus raíces, El hijo del agrimensor, publicado en mi blog personal Matemáticas en imágenes. Pero nada de eso sabía cuando comencé mis estudios de matemáticas, aunque con el tiempo he descubierto que, pese a ser el primero en la familia de mi padre en tener estudios, mi gusto por las matemáticas es parte de una herencia antigua y mi decisión, como la vida, fruto del azar y de la necesidad. Mi hijo tiene quince años y pronto tendrá que decidir qué quiere estudiar. Yo lo animo a ampliar sus opciones aprendiendo robótica, programación o neurociencia, pero soy consciente que su manera de abordar los problemas es más propia de un matemático que de un físico, un informático o un biólogo. Estudiará física, ingeniería o biología, lo que desee, pero intuyo que probablemente, tarde o temprano, se convertirá en matemático. Quizás otra vez el juego del sutil equilibrio entre azar y necesidad que rige nuestros destinos.
Pero, ¿qué son las matemáticas? Para explicar mi idea de las matemáticas, tomaré prestada la definición de William Thurston para quien las matemáticas serían algo así como la teoría de los patrones formales. Lo que Eugene Wigner definió como "la irrazonable eficacia de las matemáticas en las ciencias naturales" obedece a mi juicio al interés humano por la profundidad y la belleza de los patrones que irremisiblemente aparecen por doquier en la naturaleza y en la ciencia. Personalmente son los patrones espaciales los que más me interesan, pero no por ello me considero geómetra o topólogo, sino matemático. Si quiero entender las simetrías de un objeto, un sistema o un proceso, no me puedo contentar con aplicar mis conocimientos geométricos o topológicos, pues seguramente tendré que enfrentarme a cuestiones algebraicas, analíticas o probabilísticas. Las buenas matemáticas son imposibles de parcelar.
Muchas personas creen que las matemáticas son una disciplina árida que usa reglas complicadas y oscuras para manipular números, símbolos y ecuaciones, algo así como una rutinaria y compleja contabilidad. Sin embargo, aunque maneje números, símbolos y ecuaciones, yo no concibo las matemáticas sin imágenes y soy incapaz de pensar en un concepto matemático sin asociarle algún tipo de representación. Como sostiene Thurston, "en matemáticas, saber qué es fascinante, desconcertante, interesante, sorprendente, aburrido, tedioso, emocionante es crucial; no es accidental, sino que conforma nuestra manera de pensar." Pero lo fascinante o emocionante en matemáticas no es constante, ya que nuestro interés evoluciona con el tiempo. En mi caso, yo me inicié en la teoría de foliaciones, que aún estaba de moda en los años 1980, con un problema que treinta y tantos años después sigue sin resolver. En mi tesis, adaptaba un teorema clásico sobre simetrías de sistemas de ecuaciones diferenciales al contexto no menos clásico de la geometría de Poisson. Mis contribuciones eran básicamente una revisión de ideas y resultados de Sophus Lie, Heinz Hopf, Henri Cartan y Alexander Grothendieck, en algunos casos a través de la visión de gente como Willem Van Est o Pierre Molino. Esto es precisamente lo que más me satisface de ese trabajo, que humildemente entronca con el pensamiento de auténticos gigantes, lo que me lleva a un aspecto fundamental del trabajo científico sobre el que insistiré más tarde: en matemáticas, como en física o biología, nunca se parte de cero, sino que nuestras ideas y soluciones se nutren de las ideas y soluciones de quienes nos precedieron. La ventaja de haberme formado en el extranjero no está en el nivel o la calidad de la formación, sino en la pertenencia a una escuela y en el sentimiento que propicia esa pertenencia. Me abruma pensar que apenas once generaciones me separan de Jacob Bernoulli y ver la lista de quienes me precedieron, aunque eso me anime a contribuir haciendo perdurar esa escuela en la medida de mis posibilidades.

Fig. 1. Patrón de difracción de un casi-cristal y mosaico con simetría pentagonal descrito por Johannes Kepler en su libro Harmonices Mundi.
Mi vuelta a las foliaciones ha derivado poco a poco en un interés creciente por los sistemas dinámicos en un sentido muy amplio, lo que me ha llevado recientemente a interesarme por los procesos de invasión en redes complejas y la topología de las redes neuronales. En este viaje, no he estado, ni estoy solo. Hay una parte del trabajo matemático que es radicalmente solitaria, a veces excluyente y obsesiva. Pero hay otra parte de ese trabajo que es necesariamente colectiva y no se trata solo de la influencia de los clásicos como comentaba antes o de la necesidad de exponer ideas y resultados al conocimiento y a la crítica de otros matemáticos, sino del placer emocionante de discutir lo que uno piensa, la poca claridad que uno atisba en medio de la confusión, con colaboradores cercanos: viejos conocidos o nuevos compañeros de viaje, antiguos alumnos convertidos en pares mejores que uno mismo o jóvenes armados de un entusiasmo nuevo. Son momentos impagables que pocas profesiones ofrecen.
Y en ese viaje de la teoría a las aplicaciones, que parece una constante en el trabajo de muchos matemáticos puros y que jocosamente atribuyo a la atracción del lado oscuro de la fuerza, he descubierto un diálogo completamente nuevo para mí. El trabajo de los referees o árbitros en las publicaciones de matemáticas es particular. Con un estilo a menudo desagradable y desabrido, que nadie ha explicado mejor que Wystan Hugh Auden -¡Qué suerte la del matemático! Solo lo juzgan sus iguales y la exigencia es tan alta que ningún colega o rival poseerá jamás una reputación que no merezca-, no suele ser frecuente que los informes supongan mejoras en un artículo fuera del hecho de repensar alguna cuestión o su formulación. Sin embargo, la evaluación de mis últimos artículos en el mundo vertiginoso y despiadado de las aplicaciones me ha permitido abordar discusiones emocionantes con científicos que provienen de otras áreas como la biología o la física. En algunos casos, los comentarios y las réplicas han sido en realidad más interesantes que los propios artículos, que han terminado beneficiándose finalmente de esa dinámica. La comprensión de fenómenos complejos que ponen en juego cantidades ingentes de datos nos obliga a una revisión del modelo actual de ciencia haciendo necesaria la colaboración de especialistas con visiones complementarias o cuando menos diferentes de esos fenómenos. No se trata de que los matemáticos se limiten al análisis de los datos o contribuyan a la descripción formal de modelos o ecuaciones, sino de abordar nuevos retos de modo global. Una mirada a la interrelación entre matemática y física en el tránsito del siglo XIX al siglo XX puede ayudarnos a comprender los retos a los que enfrentamos un siglo después y al papel que sin duda jugará la biología en el desarrollo de las matemáticas del siglo XXI.
Entonces, ¿qué aportan las matemáticas? Las matemáticas aportan claridad permitiéndonos tener una visión integral y ordenada de nuestro mundo. Como les digo a mis alumnos del doble grado de Ingeniería Informática y Matemáticas, lo importante no son los enunciados concretos de los teoremas, que probablemente no necesitarán jamás, sino las ideas y estrategias que usamos para demostrarlos, con las que podemos extraer descripciones y fórmulas generales o comprender fenómenos extremadamente complejos.

Fig. 2. Probabilidad de fijación de un invasor o mutante en cada uno de los 274.668 grafos de 9 vértices expresada en función del número total de caminos que unen cada par vértices en cada grafo. El código de color permite visualizar como se distribuyen.
La importancia de teoremas como los demostrados por Andrew Wiles o Grigori Perelman no reside en sus enunciados concretos, sino en el desafío que han supuesto para el entendimiento humano. Si quieres participar en esa extraordinaria aventura, investigando en teoría de números o topología, pero también en big data, análisis de redes o neurociencia, entonces hazte matemático.
Fernando Alcalde Cuesta
Doctor en Matemáticas por la Universidad Claude Bernard Lyon 1
Profesor Titular de la Universidad de Santiago de Compostela
Una experiencia personal
Hace ya muchos años que terminé la Licenciatura de Ciencias Físicas en la Universidad Autónoma de Madrid, en la especialidad de Física Teórica, Sin embargo, al terminar estos estudios surgió la posibilidad de realizar la tesis doctoral en el campo de la Física de la Materia Condensada, abandonando la física de partículas y la cosmología, fascinantes, por un mundo igual de fascinante pero quizás con menos "glamour". Sin embargo este cambio de rumbo tuvo lugar en el momento en el que los seres humanos empezaron a desarrollar las primeras herramientas con las que mirar directamente la estructura atómica de las superficies, los Microscopios de Efecto Túnel (STM), herramientas que dieron lugar a otras muchas con las que se pueden observar átomos y moléculas e incluso manipularlos. Estas herramientas son los "ojos" con los que se empezaron a ver lo que ahora llamamos el nanomundo, siendo fundamentales para el desarrollo de lo que hemos denominado nanociencia y nanotecnología, de las que hablaré en este capítulo. Durante el doctorado y la etapa postdoctoral mi carrera se orientó hacia el estudio computacional de las propiedades electrónicas, magnéticas, y mecánicas de diversas nanoestructuras, y más recientemente he trabajado en propiedades mecánicas de virus o en la adsorción de proteínas sobre diversas superficies. Así es la actividad en ciencia, en muchas ocasiones la curiosidad nos hace seguir unos caminos a veces insospechados, pero siempre guiados por el ansia de entender cómo está constituida y cómo funciona la naturaleza que nos rodea y de la que formamos parte. Esta introducción tiene como propósito hacer reflexionar al lector sobre la belleza de toda la ciencia, en cualquiera de sus disciplinas y la continua interconexión de las mismas, y como el camino que se puede seguir cuando uno se adentra en el conocimiento puede trazar rutas no previstas inicialmente. En cualquier caso, investigar es una aventura en la que sobre todo hay que ir pertrechado con grandes dosis de curiosidad, el deseo de aprender, una pizca de paciencia, otra de perseverancia, y ganas de colaborar con otros aventureros con los que nos encontramos continuamente y cuyos descubrimientos pueden cambiar el mundo.
¿Qué es la nanociencia?
En la sección anterior ha aparecido, sin presentación, el prefijo "nano" en varias ocasiones. En ciencia, "nano" se asocia a algo pequeño, como "micro" o "pico". Sin embargo el prefijo "nano" hace referencia a la milmillonésima parte de algo (que se puede expresar como 10-9 o 0,000000001). Cuando anteponemos el prefijo "nano" a alguna unidad física podemos hablar de nanosegundos (ns) o nanómetros (nm). En concreto estos últimos son las unidades en las que me interesa detenerme un poco más. Un nanómetro es una longitud muy pequeña, en la que podemos alinear 3-5 átomos. Un virus tiene un diámetro entre 25 y 400 nm. Un cabello humano tiene un diámetro de unos 80.000 nm. Cuando hablamos de nanociencia estamos hablando del conjunto de conocimientos y técnicas que los seres humano hemos adquirido y que nos permiten comprender el "nanomundo" o la "nanoescala", refiriéndome con estos dos términos al conjunto de los materiales, estructuras y las entidades que poseen tamaños, al menos en una de sus tres dimensiones, inferiores a los 100 nanometros. Por tanto, la nanociencia tiene como finalidad entender los fenómenos que ocurren en la nanoescala, las propiedades de los materiales y las estructuras que tienen tamaños nanométricos y cómo interactúan entre ellas o con entidades de mayor tamaño.
Efectos de tamaño
La nanociencia, que requiere desarrollar habilidades e instrumentos que permiten trabajar con entidades muy pequeñas, es un campo apasionante porque cuando las partículas, las estructuras y los objetos poseen tamaño nanométrico (y los podemos llamar "nanopartículas", "nanoestructuras" y "nanoobjetos") presentan propiedades notablemente diferentes de sus "hermanos mayores".

Fig. 1. El carácter multidisciplinar de la nanociencia y el carácter transversal de la nanotecnología.
Por ejemplo, podemos encontrarnos ante hechos fascinantes como el cambio de color, o de las propiedades eléctricas o magnéticas, cuando el tamaño de los objetos decrece. Estos cambios tienen su explicación en los denominados "efectos de tamaño" que son de dos tipos: clásicos y cuánticos. ¿Cuánticos? Evidentemente, en la nanoescala se trabajan con objetos de tamaños atómicos y moleculares, en los que los efectos cuánticos se ponen continuamente de relieve. El nanomundo, además de ser más pequeño es ciertamente diferente. La nanociencia se esfuerza por entender estas diferencias, por entender que leyes siguen estos efectos de tamaño, y proponer experimentos para poner a prueba estas leyes. Por otro lado, para trabajar en el nanomundo y entenderlo se necesitan herramientas para observar y medir sus propiedades, y con lo que aprendemos se desarrollan métodos para fabricar nanoestructuras y nanoobjetos con las formas, tamaños y composición que deseemos. Esto es, en resumen, lo que se hace en los laboratorios de los centros de investigación: comprender y controlar el nanomundo.
La nanociencia: punto de encuentro
En nanociencia se trabaja con entidades muy básicas (átomos y pequeñas moléculas) que se van uniendo entre sí para formar estructuras más complejas con más funcionalidades "bottom-up" (visión "de abajo hacia arriba"). En otras ocasiones se parte de estructuras con tamaños grandes y mediante diferentes técnicas se pueden dividir de forma controlada hasta llegar a obtener nanoestructuras "top-down" (aproximación "de arriba hacia abajo"). Lo que es cierto es que las unidades de trabajo (átomos y moléculas) son las mismas para todos los científicos, independientemente de su disciplina, por eso la nanotecnología "es de todos", es multidisciplinar (Fig. 1). Cada disciplina aporta su propia jerga, sus propios métodos y técnicas, por lo que en ocasiones trabajar en nanociencia es un tanto complicado porque se mezclan ideas, conceptos, y vocabularios de diversas procedencia. Por ejemplo, un grupo de química inorgánica puede sintetizar nanopartículas, otro grupo de bioquímicos puede modificarlas para que sean capaces de detectar una determinada proteína, otro grupo de físicos puede preparar un sustrato conductor al que unir las nanopartículas con el fin de fabricar un sensor con la ayuda de un equipo de ingenieros y, finalmente, un grupo de biólogos y médicos puede someter el dispositivo a prueba con experimentos específicos. Este carácter multidisciplinar es importante para las personas interesadas en trabajar en nanociencia, pues se puede llegar a dicha disciplina estudiando diferentes grados: física, química, biología, ingeniería, etc.
Una rica fauna, una rica historia
Dado que la nanociencia se refiere a la nanoescala, el tipo de estructuras y objetos que son de interés en esta disciplina no están determinados por su composición o forma. De esta forma nos encontramos con nanopartículas, nanohilos, nanotubos, nanoláminas, etc. que pueden estar formadas por materiales metálicos, cerámicos, orgánicos, semiconductores, etc. Además estas nanoestructuras pueden combinarse entre sí para formar entidades más complejas. Parece evidente que la "nanofauna" es muy extensa y compleja. Muchos de estos nanoobjetos han saltado a la fama en los últimos años como ocurre con los fullerenos, los nanotubos de carbono, o el grafeno. Por cierto, alguno de estos materiales han supuesto el Premio Nobel para sus descubridores: el de Química en 1996 a R. Curl, H. Kroto y R. Smalley, por el descubrimiento del C60 o fullereno, y el de Física en 2010 a A. Geim y K. Novoselov, por descubrir el grafeno (verdadero material revolucionario). Sin embargo la nanociencia no es una disciplina reciente y a lo largo de los últimos 50 años se han venido realizando aportaciones desde otras disciplinas que han permitido que la nanociencia se vaya desarrollando. Se puede decir que las ideas fundamentales de la nanociencia vieron la luz gracias a la conferencia de R. Feynman impartida a finales de 1959. Por citar otro momento clave en la nanociencia se puede mencionar también el descubrimiento de Microscopio de Efecto Túnel por parte de H. Rohrer y G. Binnig (Premio Nobel de Fisica de 1986, junto con E. Ruska descubridor del Microscopio Electrónico de Transmisión).
De la nanociencia a la nanotecnología
La nanociencia tiene como fin entender y dominar las propiedades fascinantes de los nanoobjetos, nanoestructuras o nanomateriales. Estas novedosas propiedades permiten pensar en su aplicación en diferentes sectores de actividad económica. Los nanotubos y el grafeno pueden usarse en electrónica gracias a sus fabulosas propiedades electrónicas, pero también en construcción o aeronáutica gracias a sus impresionantes propiedades mecánicas, las nanopartículas de diverso tipo se utilizan en la fabricación de materiales, en cosmética, baterías, etc. Cuando se pasa de pensar en entender el nanomundo a dominarlo para obtener aplicaciones novedosas o rupturistas, la nanociencia da paso a la nanotecnología. En realidad, se puede decir que no hay sector económico en el que la nanotecnología no tenga impacto, como se pone de manifiesto en la Figura 1. Este impacto en todos los sectores económicos (se habla de impacto transversal y de nueva revolución industrial) es, sin duda alguna, lo que ha hecho que los gobiernos y las empresas de todo el mundo hayan financiado cuantiosamente muchos programas de investigación en nanociencia y nanotecnología. En otro capítulo de este libro se profundiza más sobre la nanotecnología. La llegada de la nanotecnología al mercado a su vez plantea nuevas incógnitas relacionadas con la posible peligrosidad para las personas y para el medioambiente de algunos nanomateriales, por lo que ha comenzado a desarrollar una nueva rama de investigación, la nano-eco-toxicología, que tendrá gran importancia en los próximos años.
Muchos son los caminos que llegan a la nanociencia
El camino estándar para formarse en nanociencia es seguir un grado de química, ingeniería, física, biología y medicina (adquiriendo las destrezas propias de estos campos). Se debe mencionar que la Universidad Autónoma de Barcelona puso en marcha hace varios años el Grado de Nanociencia y Nanotecnología, donde se combinan conocimientos de física, química, biología y matemáticas. Posteriormente se podría realizar un máster, de los muchos que se ofertan en nuestro sistema universitario, en el que aparezcan contenidos más específicos de nanociencia y nanotecnología. Posteriormente se puede realizar un doctorado que siga profundizando en la comprensión del nanomundo. Hay cierta polémica sobre qué tipo itinerario es mejor, con sus defensores y sus detractores para cada opción (grado generalista o grado específico), pero lo cierto es que la persona que quiera ser un nanocientífico seguro que llegará a su meta por cualquier camino. Una vez finalizada la formación como doctor, se deben seguir los caminos habituales para convertirse en un investigador consolidado bien en el sector público o en sector privado. Para llegar a ser investigador se requiere mucha vocación, paciencia, y perseverancia pero también estar al tanto de las oportunidades (convocatorias, contratos laborales) que ofertan universidades, gobiernos regionales o nacionales, y empresas. Por otro lado se espera que la administración pública y las empresas, en el caso de España, inviertan mucho más en educación, formación, investigación, generación de conocimiento y su traslado a la sociedad. Sin esta inversión, bien planificada, será imposible cambiar de modelo económico del que tanto se habla en foros económicos y políticos, pero esto es otra historia sobre la que habría mucho que hablar y que se escapa del contenido de este pequeño capítulo.
Referencias:
[1] J.A. Martín-Gago, Elena Casero, Carlos Briones, Pedro A. Serena, "Unidad Didáctica Nanociencia y Nanotecnología. Entre la ciencia ficción del presente y la tecnología del futuro." Fundación Española de Ciencia y Tecnología (2008) ISBN: 978-84-691-7266-7
[2] Pedro A. Serena, "La Nanotecnología", CSIC-La Catarata (2010), ISBN: 978-84-00-09169-9
[3] José Ángel Martín-Gago; Pedro Serena Domingo; Carlos Briones Llorente; Elena Casero Junquera, "El nanomundo en tus manos: Las claves de la Nanociencia y la Nanotecnología", Colección Drakontos, Editorial Crítica (2014). ISBN: 8498927196
[4] Pedro A. Serena, J.K. Giraldo, N. Takeuchi, J.D. Tutor (coord), "Guía Didáctica para la Educación de la Nanotecnología en Educación Secundaria" CYTED y Red NANODYF (2014). Edición en CD. ISBN: 13 978-84-15413-33-2
[5] Marta Bermejo y Pedro A. Serena, "Los riesgos de la Nanotecnología", CSIC-La Catarata (2017). ISBN: 978-84-00-10185-5
Pedro Amalio Serena Domingo
Doctor en Ciencias Físicas
Investigador Científico, Instituto de Ciencia de Materiales de Madrid (ICMM), Consejo Superior de Investigaciones Científicas (CSIC).
Durante la segunda guerra mundial y los posteriores años de guerra fría, la ciencia ficción experimentó una época dorada. En sus diversas manifestaciones (cómic, literatura y cine), se convirtió en una poderosa herramienta para plasmar las esperanzas y los miedos asociados al desarrollo tecnológico en una época de grandes transformaciones. La miniaturización fue uno de los temas que más calado tuvieron, sobre todo a partir de la novela "El hombre menguante" de Richard Matheson, publicada en 1956, de su adaptación cinematográfica por Jack Arnold un año después, y de la película "Viaje alucinante" de Richard Fleischer en 1966, que también dio pie a un libro de igual título de Isaac Asimov. Fue así, con la ciencia ficción de la era dorada, como empecé a entusiasmarme en mi adolescencia a finales de los años ochenta con la idea de trabajar con objetos a una escala minúscula. Y no sería hasta unos años después, cuando ya estudiaba Ciencias Físicas en la Universidad Complutense, que conocí la Conferencia visionaria que impartió Richard Feynman a finales de 1959: "Hay mucho sitio al fondo" [1]. En ella, el físico estadounidense ya anticipaba la manipulación atómica ("arrange the atoms the way we want"), discutía el almacenamiento en la nanoescala proponiendo guardar los 24 tomos de la Enciclopedia Británica en un objeto del tamaño de la cabeza de un alfiler, e incluso apuntaba la posibilidad de emplear nanodispositivos para la medicina ("swallow the surgeon"). Inauguraba así, de forma ilusionante, la nanotecnología, es decir, el diseño, la fabricación y la aplicación de estructuras, dispositivos y sistemas mediante el control de la forma, el tamaño y la composición a escala nanométrica.
Cabe preguntarse si la nanotecnología es un nuevo campo del conocimiento. En la naturaleza podemos encontrar ejemplos de nanoentidades que juegan un papel importante en la adaptación de especies a su entorno, como por ejemplo sucede en las alas de las cigarras, que están formadas por nanopilares (de proteínas, quitina y ceras) que le confieren dos importantes propiedades: hidrofobicidad y efecto antibacteriano [2]. Y el ser humano lleva cientos de años produciendo materiales en los que nanoobjetos provocan interesantes propiedades, como sucede en las cerámicas fabricadas en Persia en el siglo X durante la Dinastia Abasí, que presentan un efecto iridiscente producido por nanopartículas de plata precipitadas durante el proceso de cocción [3]. Sin embargo, lo que ha sucedido en las últimas décadas es que se han desarrollado herramientas que permiten visualizar esos objetos en la nanoescala, comprender los fenómenos a que dan lugar, y por último fabricarlos de forma controlada para optimizar la propiedad deseada. La nanotecnología ha sido posible gracias a los avances instrumentales, por lo que el nanotecnólogo debe seguirlos de cerca.
Los nanoobjetos pueden analizarse gracias a los microscopios electrónicos, desarrollados desde finales de los años 20 del siglo pasado, y los microscopios de sonda de barrido o SPM, surgidos en los años 80 [4]. Entre los primeros hay que distinguir entre los microscopios electrónicos de barrido o SEM (que trabajan con los electrones reflejados y/o re-emitidos y con voltajes típicos entre 1 y 30 kV) y los de transmisión o TEM (que emplean electrones que atraviesan la muestra y voltaje entre 100 y 300 kV). Entre los segundos, primero surgió el microscopio de efecto túnel o STM (que sólo podía emplearse con muestras conductoras), luego el microscopio de fuerzas atómicas o AFM, y posteriormente diversas variantes: el microscopio de fuerzas magnéticas Fig. 1. (MFM), el de fuerzas electrostáticas (EFM), el de fricción (SFFM), el de potencial superficial (KPFM), el de campo cercano (SNOM), etc. Combinando las técnicas de microscopía electrónica con las de sonda de barrido y con las nuevas técnicas de microscopía óptica de súper-resolución, no sólo se puede estudiar la morfología de los materiales en la nanoescala, sino que se tiene acceso a la composición química, a la estructura cristalina, y a la medida de diversas propiedades: electrónicas, magnéticas, mecánicas, ópticas…

Fig. 1. Imagen de un disco duro de ordenador obtenida con un microscopio de fuerzas magnéticas (MFM). Los rectángulos rojos o azules son los bits de información ("unos" o "ceros").
En cuanto a la fabricación de nanoestructuras, cabe distinguir dos aproximaciones denominadas descendente y ascendente:
-Por un lado, al igual que un escultor emplea cincel y martillo para sacar formas de un bloque de piedra, en la vía descendente (top-down) se emplean diversas herramientas para miniaturizar o moldear desde lo macroscópico. Las técnicas más empleadas en la aproximación descendente son la molienda, el ataque por iones, y diversos tipos de litografía: por luz ultravioleta (se usan longitudes de onda más cortas para hacer cosas cada vez más pequeñas, hoy en día ya se emplea el ultra-violeta extremo), por electrones, por haz de iones, o por nanoimpresión.
-Por otro, a semejanza del aficionado a Lego que construye casitas uniendo pequeñas piezas, en la vía ascendente (bottom-up) se ensamblan nanoentidades (átomos, moléculas), ya sea de forma forzada, ya mediante procesos de autoensamblado. En lo que respecta a la aproximación ascendente, las técnicas más conocidas son la síntesis química, la síntesis electroquímica, la manipulación por SPM, los procesos sol-gel, y las diversas técnicas de condensación desde fase vapor: la deposición química de vapor (CVD), la deposición de capas atómicas (ALD), la epitaxia de haces moleculares (MBE), la ablación láser (PLD), y la pulverización catódica (sputtering).
Todo este conjunto de técnicas permite fabricar de forma controlada diversas nanoestructuras que podemos clasificar por el número de dimensiones que poseen en la nanoescala:
-Con una dimensión, el espesor, se preparan láminas delgadas y ultra-delgadas. Los discos duros de ordenador o los paneles fotovoltaicos son ejemplos de este tipo de láminas, en muchos casos formados por varias capas de composición y espesores distintos (y entonces se las denomina "multicapas").
-Con dos dimensiones se fabrican nanotubos, nanohilos, nanopilares y biopolímeros. Por ejemplo, los nanotubos de carbono son ligeros y muy resistentes, por lo que ya se emplean en la fabricación de raquetas de tenis y palos de golf y se está investigando su uso en materiales para aeronáutica.
-Con las tres dimensiones nanométricas se producen fulerenos, nanopartículas, puntos cuánticos, dendrímeros y liposomas. A modo ilustrativo, cabe mencionar que estos últimos son esferas que se emplean como transportadoras de medicamentos en diversas terapias contra el cáncer.
Conviene asimismo señalar que todos estos materiales pueden ser susceptibles de "funcionalización", esto es, de ser modificados en su superficie e incluso combinarse para dotarles de nuevas funciones o conseguir una mejora de alguna de sus propiedades. Así, las nanopartículas suelen recubrirse con surfactantes para impedir que se aglomeren. Y en los sensores de gases basados en la resonancia de plasmón de una lámina delgada de oro, ésta se funcionaliza con una capa porosa (por ejemplo formada por nanopilares de dióxido de titanio) que capta las especies que se desea detectar.
Como acabamos de ver en los ejemplos anteriores, la nanotecnología ya tiene aplicación hoy en día en tres grandes sectores: tecnologías de la información y las comunicaciones, energía y medioambiente, ciencias de la salud y biotecnología [5,6]. Y en ocasiones, un mismo tipo de nanoestructuras puede ser útil en todos ellos. Por ejemplo, nanoestructuras con propiedades antibacterianas pueden emplearse en dispositivos de reconocimiento de huella para impedir la propagación de infecciones en un centro de trabajo, en dispositivos de tratamiento de aguas y en implantes medicinales.
En mi caso particular, he llegado a trabajar en nanotecnología desde la Física, esto es, desde el estudio de las entidades elementales de materia que podemos manipular (los átomos) y de sus diversas interacciones. Pero puede llegarse a la nanotecnología desde otros campos del saber. Tanto el desarrollo instrumental como los materiales que forman las nanoestructuras pueden abarcarse desde la Ingeniería. Dado que en los sistemas nanométricos cobran especial importancia las superficies y las intercaras donde comienzan las reacciones, la Química también es una buena base desde la que construir una carrera profesional en nanotecnología. Como también lo son la Biología, la Farmacia y la Medicina, puesto que esos sistemas van a relacionarse con entidades biológicas de unos pocos nanómetros (moléculas orgánicas), de centenares de nm (virus y bacterias) e incluso de miles de nm (células). Y tampoco hay que olvidar que la Informática y las Matemáticas pueden proporcionarnos poderosas herramientas de cálculo para modelizar las propiedades en la nanoescala. Llegamos así a un hecho indudable: la nanotecnología es un campo eminentemente multidisciplinar. Por ello, el nanotecnólogo no sólo debe informarse de los recientes avances en su campo de especialización, sino que debe diversificar su atención, estar atento a los descubrimientos en otras áreas y, en la medida de lo posible, asistir a congresos que le permitan abarcar otras disciplinas. Asimismo, es necesario que consiga crear una red de colaboración que pueda hacer frente a los distintos retos científico-tecnológicos que encuentre en su labor investigadora, pues será difícil que pueda resolver todos por sí solo. Y por último, pero no por ello menos importante, debe ser consciente de los posibles riesgos que puedan ocasionar la fabricación y el uso de los nanomateriales. La nanotecnología puede mejorar el mundo en muchos aspectos, pero sólo si se trabaja en ella con entusiasmo y responsabilidad.
Referencias:
[1] Richard Feynman: "There'sPlenty of Room at the Bottom", conferencia impartida en Caltech el 29 de Diciembre de 1959,http://calteches.library.caltech.edu/47/2/1960Bottom.pdf
[2] E. P. Ivanovaet al., "Natural Bactericidal Surfaces: Mechanical Rupture of Pseudomonas aeruginosa Cells by Cicada Wings", Small 16, 2489 (2012)
[3] D. Erhardt: "Materials conservation, not-so-new technology", Nature Materials 2, 509 (2003)
[4] El Premio Nobel de Física de 1986 reconoció estos descubrimientos: fue compartido entre Ernst Ruska, que construyó el primer microscopio electrónico de transmisión, y Gerd Binnig y Heinrich Rohrer, co-inventores del microscopio de efecto túnel:
[5] Unos pocos ejemplos en: J.M. García Martín, "¿Qué son la nanociencia y la nanotecnología? ¿Cómo afectarán a nuestras vidas?", Capítulo 68 del Libro "CIENCIA, y además lo entiendo!!!" (Ed.: Q. Garrido Garrido):http://divulgacioncientificadecientificos.blogspot.com.es/p/libro-book.html
[6] Y más ejemplos en este excelente ensayo divulgativo: "La nanotecnología", Pedro Serena, Los Libros de la Catarata (2010)
José Miguel García-Martín
Doctor en Ciencias Físicas
Investigador Científico, Instituto de Micro y Nanotecnología, CSIC
La física es probablemente la ciencia más sexy de todas, la que más llama la atención, crea más debate y atrae más al público por su complejidad, por lo alocadas que parecen algunas de sus ideas, y por qué no decirlo, por la serie The Big Bang Theory. Cuando pensamos en temas relacionados con la física, nos viene a la cabeza la astrofísica, la cosmología, la física nuclear, el electromagnetismo o incluso la termodinámica, pero prácticamente nunca la óptica. ¿Óptica? ¿No es eso lo que estudian quiénes nos revisan la vista y nos hacen las gafas? ¿Qué tiene que ver exactamente con todo eso con la física?
Ciertamente, cuando yo mismo empecé la carrera, lo que quería era conocer los entresijos del universo, dominar la relatividad general, acabar siendo un experto en teoría de cuerdas, pero lo que nunca se me pasó por la cabeza era ser óptico. Más que nada, porque no tenía ni idea de qué englobaba la óptica. La óptica tampoco me conquistó en 3º de carrera, cuando estudiamos óptica geométrica, que es fundamentalmente la óptica que se estudia en óptica y optometría -esta sí es la carrera que necesaria para saber el funcionamiento de la vista y cómo corregir sus deficiencias. No obstante, el último año de carrera hubo una asignatura muy concreta que cambió mi percepción sobre la óptica y me enseñó lo que la óptica nos ofrece: óptica cuántica. Pero para entender el porqué de ese cambio, primero debemos entender qué es exactamente la óptica.
¿Qué es la óptica?
La óptica (o fotónica, como se le viene llamando desde hace unos años) es la ciencia que estudia la luz, las tecnologías basadas en la luz y cómo ésta interacciona con la materia. Por tanto, primero hay que entender qué es la luz.
La luz visible -que puede ser percibida por el ojo humano-es un tipo de radiación electromagnética, es decir, es una onda electromagnética (si nos olvidamos por el momento de la física cuántica), cuya longitud de onda (λ) va desde los 400 nanómetros (ultra-violeta cercano) hasta los 800 (infra-rojo cercano) nanómetros aproximadamente. Aun así, en física se acepta englobar dentro del concepto luz también a los rayos X blandos (λ = 0.1 nanómetros) y al infra-rojo lejano (λ = 1500 nanómetros). Como toda onda, la luz tiene asociada además una cierta frecuencia  y una velocidad de propagación c, de tal forma que
y una velocidad de propagación c, de tal forma que  . Así, la óptica se encarga de estudiar la generación, control y aplicaciones de la luz, desde las más puramente tecnológicas, como la impresión 3D, hasta la captura de átomos individuales o la criptografía cuántica, que se basa en el comportamiento cuántico de la luz, esto es, en el uso de fotones.
. Así, la óptica se encarga de estudiar la generación, control y aplicaciones de la luz, desde las más puramente tecnológicas, como la impresión 3D, hasta la captura de átomos individuales o la criptografía cuántica, que se basa en el comportamiento cuántico de la luz, esto es, en el uso de fotones.
De hecho, la concepción de que la luz es emitida en pequeños paquetes de energía  (donde
(donde  es la constante de Planck y
es la constante de Planck y  es la frecuencia de la luz), conocidos como fotones, fue una de las primeras grandes demostraciones de que la física cuántica es una realidad, lo que le valió a Albert Einstein el premio Nobel en 1921 por su explicación del efecto fotoeléctrico.
es la frecuencia de la luz), conocidos como fotones, fue una de las primeras grandes demostraciones de que la física cuántica es una realidad, lo que le valió a Albert Einstein el premio Nobel en 1921 por su explicación del efecto fotoeléctrico.
Puede parecer que considerar la luz como una partícula sea una idea muy revolucionaria, pero este concepto es mucho más antiguo de lo pueda parecer. De hecho, siempre me gusta hacer un ejercicio de reflexión muy sencillo: piensa en una bombilla iluminando una habitación y piensa cómo ves esa bombilla, como tus ojos captan su luz.
Si pones un trozo de papel oscuro entre la bombilla y tu ojo, ya no puedes ver más esa luz. La única luz que te puede llegar es la que está rebotando en las paredes de la habitación. Por tanto, parece que la luz viaja en línea recta. Además, ¿cómo nuestros ojos pueden captar la luz?

Fig. 1. La luz está formada por una parte muy pequeña de radiación dentro del espectro electromagnético.
Lo más intuitivo sería decir que la luz está formada por pequeñas partículas, cada una de un color y que tenemos diferentes receptores que interactúan con esos diferentes colores, por ejemplo. Además, si la luz es una onda, ¿a través de qué medio se propaga? Por el aire no puede ser, puesto que sabemos que la luz viaja por el espacio vacío. Así, a primera vista es muy difícil decir que la luz pueda ser una onda. Todas estas preguntas se las habían hecho filósofos desde la Edad Antigua hasta bien entrado el siglo XVII. Es más, Isaac Newton fue uno de los grandes defensores de la teoría corpuscular de la luz, ayudando a establecer todo un conjunto de leyes para los fenómenos ópticos conocidos. Solo había un par de fenómenos para los cuales no se tenía una buena explicación si se consideraba que la luz era una partícula: la difracción producida por un obstáculo circular y la refracción en cristales biáxicos (que, por cierto, fueron el tema central de mi tesis doctoral). Estos dos fenómenos fueron los que inclinaron la balanza a principios del siglo XIX hacia la teoría ondulatoria de la luz e hicieron que la teoría corpuscular cayera en el olvido hasta que la física cuántica la recuperó. Personalmente, todos estos conceptos de la luz fueron los que me atraparon definitivamente y me encaminaron hacia ser un científico que estudia la luz desde el punto de vista fundamental y las muchas aplicaciones que se derivan de ella.
La óptica en nuestro día a día
¿Cuáles son esas aplicaciones de las que tanto hablo? Para hacernos una idea de la magnitud de la óptica en nuestras vidas y en la ciencia, solo decir que en los últimos 25 años se han dado 10 premios Nobel (7 en Física y 3 en Química) a avances científicos y tecnológicos basados en la luz. Uno de los elementos más comunes a todos estos avances es el uso del láser (Light Amplification by Spontaneous Emission of Radiation o amplificación de luz por emisión estimulada de radiación) y no es por casualidad que también sea la tecnología fotónica que más versátil es en nuestras vidas. La luz láser, cuyo funcionamiento solo puede ser entendido mediante la mecánica cuántica, tiene dos propiedades que la hacen única: alta coherencia temporal, relacionada con el rango de longitudes de onda contenidas en la emisión de luz, que en el caso del láser son muy estrecho; y alta coherencia espacial, relacionada con la direccionalidad de la emisión; en otras palabras, que la luz láser sea de un solo color y funcione a modo de puntero. Estas propiedades hacen que el láser pueda ser utilizado como lector de códigos de barras en el supermercado, como lector/grabador de discos compactos como CDs, DVDs o Blue-Ray discs; como elemento de corte en la empresa textil, metalúrgica y en medicina; en impresión 3D de materiales polimerizables (como algunas resinas), en topografía (para estudiar el relevo del terreno), en comunicaciones (ya sea por fibra óptica como por el espacio libre, como entre dos satélites, por ejemplo), en medición de distancias, y la lista podría continuar.

Fig. 2. Ejemplos de tecnologías ópticas: impresión 3D basada en polimerización a 2 fotones; operaciones oftalmológicas con láser; comunicaciones Tierra-satélites; faros LED de un coche.
Obviamente, otra área en la que la óptica destaca es en el diseño de lentes ya sea para gafas, para cámaras u otros sistemas de imagen, para lentes intraoculares, o en el estudio general de la visión humana. La optometría y la óptica de la visión es un campo que está avanzando muy rápidamente durante los últimos años y en el que en España tenemos grandes expertas y expertos mundiales. Y tampoco me gustaría olvidar a los LEDs (Light Emiting Diode o diodo emisor de luz), que están cada vez más introducidos en la iluminación tanto de nuestras casas como de ciudades y que también están siendo muy usados en pantallas publicitarias.
El día a día de un óptico: una perspectiva personal
Como ya he comentado más arriba, mis inicios como científico estuvieron ligados al estudio de la propagación de la luz en cristales biáxicos, que son unos tipos de cristales (se pueden encontrar en la naturaleza en forma de mineral o pueden ser producidos artificialmente) que dividen el haz de luz inicial en dos haces que se propagan en direcciones distintas dentro del cristal y emergen con polarizaciones ortogonales, un fenómeno conocido como refracción doble. Cambiando el ángulo de incidencia del haz de entrada, cambia la separación entre los dos haces, hasta que para ángulo muy concreto éstos se unen formando un anillo de luz, fenómeno conocido como refracción cónica. Lo más bonito de esta fenomenología es que permite estudiar todas las propiedades físicas de la luz como la polarización o algunas menos conocidas como el momento angular de espín y momento angular orbital. Todas estas propiedades de la luz se entrelazan y son modificadas por los cristales biáxicos, lo que me ha dado una perspectiva amplia de los fundamentos físicos de la óptica y me ha permitido aplicarlo a nuevos sistemas de telecomunicaciones ópticas, a la captura y manipulación de macropartículas (tan grandes como el grueso de un cabello) y átomos ultra-fríos y, actualmente, a la microscopía de dos fotones (TPM, Two-Photon Microscopy). TPM es un tipo de microscopía de fluorescencia utilizada comúnmente en neurociencia para ver la actividad neuronal de un animal. Para ello, típicamente se modifica genéticamente el ADN del animal en cuestión, introduciendo una proteína fluorescente que se manifiesta en ciertas partes del cuerpo (en mi caso, en zonas escogidas del cerebro). Cuando la neurona donde se halla la proteína se activa, la proteína también pasa a activarse y emite luz cuando es iluminada con un láser de una cierta longitud de onda. Dicho de otro modo, se puede observar la actividad neuronal a través de la fluorescencia de la proteína. Se llama microscopía de dos fotones, porque la proteína necesita absorber dos fotones de una misma longitud de onda para pasar a su estado excitado y emitir fluorescencia. En realidad, lo mismo se podría hacer con un solo fotón a otra longitud de onda, pero el resultado sería el de una resolución menor.

Fig. 3. Izquierda: la microscopía de fluorescencia nos permite ver la actividad neuronal de animales; en la imagen, el cerebro de una mosca de la fruta. Derecha: una rata con una fibra óptica implantada en el cerebro para manipular ópticamente sus neuronas mediante optogenética.
Alternativamente, también se puede hacer el proceso opuesto: inducir un estado activo en la neurona solo cuando la proteína absorbe luz, técnica que se conoce como optogenética y que ha servido, por ejemplo, para crear recuerdos artificiales en ratones. Todo esto son ejemplos para mostrarte en casos prácticos que utilizando la óptica he podido estudiar una gran variedad de temas distintos de investigación.
A modo de conclusión
La óptica es una disciplina propia de la física que es indispensable tanto para nuestro día a día como para el avance de la ciencia en todas las áreas de la ciencia que van desde la criptografía cuántica hasta la neurociencia, pasando por la química, la biología, la astronomía, etc. Esto hace de la óptica una ciencia muy versátil y atractiva de estudiar y ha hecho que mi profesión como científico sea muy agradecida, al poder ayudar a dar soluciones a problemas reales, a la vez que me lo he pasado en grande aprendiendo de todos ellos.
Referencias
[1] Alonso, B., Borrego, R., Hernández-García, C., Pérez, J. A., Romero, C. Eds. (2011), El láser: la luz de nuestro tiempo, Globalia. Accesible online: http://optica.usal.es/gioe/images/El_laser.pdf
Alejandro Turpin
Doctor en Física, Investigador en el Center of Advanced European Studies and Research en Bonn, Alemania.
Doscientos mil demonios
de su furia infernal den testimonios,
volviéndose inclementes
doscientas mil serpientes
que asiéndome de un vuelo
den conmigo de patas en el cielo,
del mandato oprimidos
de Dios, por justos juicios compelidos,
si vivir no quisiera, sin injurias
en Galicia o Asturias
antes que en esta corte [1].
Agosto de dos mil diecisiete. Algún lugar del norte de España. Llueve intensamente. Solo en casa, pienso que es el momento óptimo para escribir. No en vano, Quintín me había encargado hacía unas semanas escribir un capítulo de su libro. Acepté el encargo con gran gusto, pensando que sería sencillo escribir sobre un tema que me parece tan apasionante como la probabilidad. Sin embargo aquí estoy, con una página que continua en blanco. Me reclino sobre la silla, noto como su respaldo de madera se clava en los huesos de mi espalda mientras miro a través de la ventana como la lluvia sigue cayendo. Balanceo el bolígrafo entre mis dedos sobre el papel impoluto mientras recuerdo la conversación que unos turistas mantenían uno de estos días: "No volvemos, ¡aquí siempre está lloviendo!". En definitiva, es una tarea imposible: ¡a nadie le gusta la probabilidad! Ciertamente, la mayoría de la gente quiere explicaciones sencillas, no argumentos probabilistas. El repiqueteo de las gotas de lluvia contra el cristal de la ventana me saca súbitamente de mi ensoñación, pero miro hacia abajo y el papel sigue en blanco. En fin, imposible.
Dos veces, dos, has tenido
ocasión para jugarte
la vida en una partida,
y las dos te la jugaste [2].
Juegos de azar
Los seres humanos han desarrollado y practicado juegos de azar a lo largo de los siglos. El estudio sistemático de los mismos, con el objetivo de obtener ventaja sobre los rivales, está relacionado con el origen de la teoría de la probabilidad. No en vano ejemplos y ejercicios ilustrados con juegos de azar son muy comunes en los cursos de probabilidad. Entre ellos se podría decir que destaca en cierto modo el problema de Monty Hall [3]. Podemos explicarlo brevemente de la siguiente manera: un concursante en un programa de televisión tiene que elegir una puerta entre tres. Detrás de dos se encuentran sendas cabras y detrás de la tercera un coche. A falta de más información el concursante escoge una de las tres puertas al azar. En ese momento el presentador abre una de las dos puertas restantes y muestra una cabra. A continuación da la oportunidad al concursante de cambiar de puerta, ¿debería hacerlo? Contra lo que la intuición parece sugerir, sí debería hacerlo para maximizar sus posibilidades de ganar el coche; concretamente las doblaría si cambiase su elección original. Podemos volver a ilustrar la importancia de un estudio sistemático de las probabilidades en los juegos de azar con una versión un poco más sofisticada de este ejemplo. Supongamos que tenemos tres cajas con dos monedas cada una: en una caja hay dos monedas de tres peniques, en otra dos monedas falsas (que no valen nada) y en la tercera una de cada, y asumimos que las cajas son indistinguibles.

Fig. 1. Dados de 4, 6, 8, 10, 12 y 20 caras con los que practicar diversos juegos de azar.
Nos enfrentamos a otro jugador que escoge al azar una de las tres cajas, tras lo cual nosotros elegimos al azar una de las dos restantes. Lo que haya en nuestra caja es lo que ganaremos. Una vez escogidas las cajas nuestro rival extrae al azar una moneda de la suya y nos la muestra: es una moneda de tres peniques. En este momento el moderador del juego nos ofrece dos peniques por nuestra caja, ¿qué deberíamos hacer? Un análisis de la situación revela que deberíamos aceptar la oferta, aunque iguala en magnitud a la recompensa esperada, tiene la virtud de reducir el riesgo. ¿Y si cambiásemos las reglas para que solo el mayor premio se materializase? Entonces aún con más razón deberíamos aceptar los dos peniques, porque la probabilidad de quedarse sin nada sería alta. Dejamos al lector los detalles del análisis, para que así aprecie mejor el desarrollo de los argumentos probabilistas.
A pesar de que estos ejemplos ilustran cómo la probabilidad puede ayudarnos en los juegos de azar (aun siendo ejemplos teóricos), su estudio sigue sin ser popular. Más al contrario, es muy común ver que ciertos argumentos totalmente falsos se repiten una y otra vez. Un ejemplo paradigmático tiene lugar durante las fechas prenavideñas debido a la popularidad de los sorteos de lotería. Argumentos tales como que unos números tienen mayor probabilidad de salir que otros (que ya han salido, o que no son "bonitos", signifique lo que signifique este concepto en este contexto) o que los décimos comprados en ciertos lugares tienden a ser más favorecidos por la suerte carecen de cualquier rigor científico y son sin embargo empleados de forma recursiva.
Pero aun bien no lo he creído
porque cosa extraña fuera
que un hombre a Madrid viniera
y hallase recién venido
una dama que rogase
que su vida defendiese,
un hermano que le hiriese,
y otro que le aposentase.
Fuera notable suceso
y, aunque todo puede ser,
no lo tengo de creer
sin vello [1].
Los sucesos extremos existen
Acostumbrados como estamos a la cotidianeidad del día a día los sucesos poco frecuentes nos puede parecer algo desde sorprendente hasta molesto. Es habitual que se intenten encontrar motivos para que estos sucesos hayan tenido lugar, pero su origen puede ser de naturaleza aleatoria. Entre estos sucesos se encuentran los fenómenos meteorológicos extremos y las extinciones masivas de poblaciones, o bien la aparición de plagas.

Fig. 2. Una moneda de tres peniques como las usadas en nuestro juego de azar.
Es muy común encontrar en estos tiempos opiniones sobre los días veraniegos de calor duro, relativamente frecuentes en gran parte del país, relacionadas de una manera u otra con el cambio climático. Sin embargo, los fenómenos meteorológicos extremos siempre han estado presentes a lo largo de la historia, y prolongadas sequías, inundaciones o inviernos anormalmente largos aparecen descritos en los diferentes siglos. Luego la aparición de un suceso tal no indica más que la naturaleza aleatoria del clima. Sin embargo, un aumento de la frecuencia con la que aparecen sucesos meteorológicos extremos sí podría estar emparentado con un cambio climático [4], lo que nos aboca necesariamente a un estudio probabilista cuantitativo de la situación. En general, la naturaleza aleatoria del tiempo meteorológico suele provocar un cierto despiste en algunas personas. La predicción meteorológica siempre es probabilista y uno no puede tomarla como infalible. De la misma manera, el hecho de haber estado unos días en una ciudad y haber encontrado lluvia, frío o calor excesivo no es sinónimo de que ese sea el clima usual allí: de nuevo conviene resaltar que la variabilidad meteorológica puede ser enorme.
Como ya hemos mencionado, la aleatoriedad también es inherente a muchas facetas de las poblaciones biológicas; y no solo extinciones y plagas pueden aparecer por azar. La evolución biológica está fuertemente determinada por las mutaciones aleatorias, que pueden ser seleccionadas de manera natural o neutra [5], dando la segunda opción más peso al azar que a las ventajas selectivas. De la misma manera, hay fenómenos de diferente naturaleza que pueden tener un origen puramente aleatorio, como las crisis financieras o las expansiones económicas; y en ambos casos es usual encontrarse colectivos que se afanan por explicarlas por medio de causas simples. Dicho esto, es importante resaltar que no todas las crisis económicas, fenómenos meteorológicos o sucesos extremos en general están causados por el azar. Frecuentemente unas pocas causas, sencillas y bien definidas, están en la base de tales sucesos. Lo que en ocasiones olvidamos es que, además de estos sucesos, más previsibles y evitables, están los que tienen en el azar su origen. Para entender el impacto que pueden llegar a tener estos últimos no cabe más que un estudio cuantitativo de sus probabilidades, estudio que puede también llevarnos a comprender con mayor profundidad sucesos ya acontecidos.
En conclusión
Hemos comentado unos pocos ejemplos de casos en los que la teoría de la probabilidad puede arrojar luz sobre hechos científicos o sucesos cotidianos. Realmente hay muchísimos ejemplos más que van desde la mecánica cuántica hasta la valoración de productos financieros. Un hecho particularmente interesante acerca de la teoría de la probabilidad es, en mi opinión, su capacidad de contradecir el pensamiento mágico o pseudocientífico. Por poner un último ejemplo, como una matrona me comentó hace tiempo, parece que hay días que nacen muchos bebés y días que no nace ninguno. Es decir, que los nacimientos se distribuyen en el tiempo de forma poco homogénea. Este hecho ha dado lugar a diferentes teorías pseudocientíficas sobre qué días es más probable que nazca un bebé. Sin embargo, se puede encontrar una explicación meramente probabilista: el hecho de que los nacimientos se produzcan homogéneamente repartidos en el tiempo es muy poco probable. De nuevo, tal y como hemos comentado anteriormente, parece que se trata de una explicación poco popular y que las teorías pseudocientíficas siguen prevaleciendo sobre las probabilistas en este respecto en al menos parte del imaginario popular. Finalmente, ¿cómo puede saber alguien si le gustaría ser probabilista? Si los temas mencionados en este capítulo le resultan de interés es posible que le gustase internarse más profundamente en la teoría de la probabilidad. Si los problemas planteados le resultan atractivos y no rompecabezas sin mucho sentido entonces puede avanzar sin miedo en la disciplina. A lo largo del tiempo me he encontrado personas que se sentían atraídas por la probabilidad. En unos casos por sus aplicaciones en diferentes campos, como la física o la biología, o simplemente por la intrínseca belleza matemática de esta materia. Pero puestos a resumir experiencias creo que los juegos de azar y las aplicaciones financieras han tenido un papel destacado entre las motivaciones que la gente ha tenido a bien contarme a lo largo de los años. Y es que a día de hoy sigue siendo posible sacar ventaja en unos y otras mediante estudios probabilistas sistemáticos de los casos particulares de interés, máxime habida cuenta la escasa popularidad de la que, en mi opinión, goza esta disciplina. ¿Y respecto a mi experiencia personal? Sin duda muchas de las cuestiones que he mencionado me han atraído a lo largo del tiempo, y esa es una de las razones por las que me gusta la probabilidad. Pero para ser honesto he de añadir que hay muchas otras cosas que me han gustado también, y sin embargo no les he dedicado mi trabajo. Creo que, a fin de cuentas, ha sido un proceso fuertemente aleatorio el que me ha llevado a la teoría de la probabilidad.
Por no malograr el tiempo;
que en estas cosas se gasta,
pudiéndolo aprovechar
en pedir de nuestras faltas
perdón, humilde el autor
os le pide a vuestras plantas [1].
Notas:
[1] La dama duende, Pedro Calderón de la Barca.
[2] Poesías de la guerra española, Pedro Garfias Zurita.
[3] Mathematical Games,columna de Scientific American, Martin Gardner,octubre de 1959,pp.180–182.
Carlos Escudero Liébana
Doctor en Ciencias Físicas
Departamento de Matemáticas, Universidad Autónoma de Madrid
Quiero ser profesora de física recuerdo que me decía mi amiga Isabel cuando en el sexto curso de Bachillerato Superior de Ciencias hacíamos juntas las tareas que nos mandaba el profesor de física del colegio privado donde estudiábamos. ¿Qué significaba ser profesora de física? ¿Qué se requería para ser buena profesora? me preguntaba yo mientras buscábamos afanosamente la fórmula que teníamos que aplicar para resolver el problema. En aquel curso me conformaba con entender las explicaciones del profesor y saber resolver los ejercicios que teníamos mi amiga y yo entre manos. En síntesis, yo lo que quería entonces era aprender física, pero ¿Cómo podría yo aprender y saber física?
¿Cómo se aprendía física en la enseñanza tradicional?
Tras la reválida de sexto, hice el curso preuniversitario.

Fig. 1. El papel del profesor en un modelo clásico de enseñanza
En el "Preu" cursé la asignatura de física, con un programa muy extenso orientado a la prueba de acceso a la Universidad, que el profesor seguía con el libro de texto de Santiago Burbano Ercilla.
Como alumna de licenciatura ya pude apreciar que un profesor excelente puede hacer bueno un programa malo de estudios y viceversa, el mejor plan de estudios está abocado al fracaso en manos de profesores ineptos. En todas las asignaturas de la carrera de Físicas en la Universidad de Valladolid, se seguía un sistema tradicional de enseñanza (se conoce como pasivo) cuyo principal objetivo era la adquisición del conocimiento, en el que los profesores usaban el método de lección magistral (Fig. 1) y resolución de ejercicios y problemas, en las dos modalidades de clases teóricas y clases prácticas, además de las tutorías. Los profesores que me daban clase desarrollaban todas las demostraciones en la pizarra y los alumnos estudiábamos por apuntes que tomábamos en clase, por libros recomendados en cada asignatura (entre otros: Sears Zemansky, Aguilar Peris, Goldstein, Alonso Finn, Reitz Milford, Messiah) y por apuntes elaborados por los profesores. Como alumna inquieta intelectualmente yo asistía a seminarios y conferencias y adquiría o me prestaban algún libro extranjero sobre todo de problemas.
Soy profesora de física en la universidad desde que terminé mis estudios (hace muchos años) y me he podido responder las preguntas que en mi juventud me hacía, y ahora me toca responder a las que se me hacen. Casualmente este verano una destacada alumna en la última olimpiada de física, también me ha dicho que quiere ser lo mismo que mi amiga y que está muy interesada en saber qué significa ser profesora de física y ser una buena profesora. Sus inquietudes son las mismas que fueron las mías y eso me motiva a transcribir a continuación una breve descripción de las respuestas que daré a la joven estudiante.
¿Qué es ser profesora de física y para qué sirve?
En general, ser profesor de física va mucho más allá que enseñar los contenidos científicos de la materia y evaluar que los estudiantes los hayan adquirido. En la educación superior, en particular, ha de estar capacitado para desempeñar correctamente las tres funciones que le son encomendadas: la docencia, la investigación y la gestión. Respecto a la primera de estas funciones, desde la incorporación al EEES en el curso 2009-10, la docencia en general y de la física en particular, ha asumido un nuevo paradigma centrado en el trabajo del estudiante (con la necesaria ayuda del profesor como facilitador de su aprendizaje) y el nuevo modelo competencial en el que las competencias constituyen el núcleo del proceso de enseñanza y aprendizaje.

Fig. 2. El profesor eslabón de la transmisión del sabe.
Por eso, el profesor de física ha de planificar la metodología del proceso de enseñanza-aprendizaje (las modalidades, los métodos de enseñanza y los sistemas de evaluación) de sus materias de Grado y de Máster, teniendo en cuenta las competencias establecidas. He de comentarla que estoy de acuerdo con los autores que afirman que de los cuatro perfiles que distinguen del profesor universitario (investigador puro, investigador pragmático, docente y comunitario), el perfil docente posee una verdadera vocación universitaria, siente un gran interés y motivación por la docencia, a la que dedica mucho tiempo y esfuerzo, le gusta la relación con sus alumnos y le preocupa que los alumnos tengan un aprendizaje de calidad y formar a buenos profesionales [1].
Una de las vías de transmitir la ciencia a la sociedad (Fig. 2) es mediante la actividad académica (la educación científica reglada) a estudiantes en diferentes niveles educativos; y le expresaré que los profesores de física constituyen el eslabón imprescindible y principal de transmisión de ese saber entre los científicos y la sociedad [2]. Recordando las muy sabias palabras de Ilya Pregogine durante Conferencia en el Forum Filosófico de la UNESCO en 1995, le diré a esta alumna que deberá estar siempre dispuesta a ampliar su conocimiento [¿Qué es lo que no sé? Esta pregunta me hace pensar en otra pregunta, que se puede considerar complementaria: "¿qué es lo que sé?". Mi respuesta a esta pregunta está clara: muy poco. No digo esto por modestia excesiva, sino por una convicción profunda: nos encontramos al final de esa era de la historia de la ciencia que se abrió con Galileo y Copérnico. Un período glorioso en verdad, pero que nos ha dejado una visión del mundo demasiado simplista. La ciencia clásica enfatizaba los factores de equilibrio, orden, estabilidad. Hoy vemos fluctuación e inestabilidad por todas partes. Estamos empezando a ser conscientes de la complejidad inherente del universo. Esta toma de conciencia, estoy seguro, es el primer paso hacia una nueva racionalidad. Pero sólo el primer paso].
Cuando sea profesora esta jovencita, podrá enseñar tantos y tan importantes aspectos de qué son y para qué sirven las diferentes áreas de esta ciencia….Que la física es soporte de otras disciplinas científicas y de numerosas aplicaciones tecnológicas en amplios campos de la actividad humana. Mediante la enseñanza de esta ciencia básica podrá facilitar a sus alumnos la comprensión del mundo en su complejidad mediante una estructura formal, desde la elaboración de modelos simplificados hasta la aportación de enfoques más aproximados al problema complejo. En sus actividades docentes de transmisión del conocimiento, podrá utilizará los métodos de razonamiento propios de esta ciencia ligados con la descripción de fenómenos físicos, de sus leyes y principios, a través de un lenguaje específico como es la formulación matemática. Por tratarse la física de una materia dinámica, podrá explicar en cada nivel de estudios diversas y adecuadas construcciones teóricas que no son dogmáticas ni definitivas.
¿Cómo ser una buena profesora de física?
Siempre deberá enseñar a sus estudiantes a aprender a aprender, a pensar, a reflexionar y criticar constructivamente y como profesora de física tendrá que ser altamente competente. En particular, las competencias que ha de desarrollar una profesora de física en la educación superior [3] son entre otras: Conocer y saber aplicar los contenidos curriculares de la materia/s concretas de física. Conocer el contexto universitario y saber desenvolverse en él. Trabajar en equipo con personas del mismo y de distinto ámbito profesional. Conocer y saber aplicar metodologías docentes innovadoras. Evaluar el proceso de enseñanza-aprendizaje. Organizar y gestionar eventos científicos [4]. Destaco aquí que la profesora de física ha de tener inquietud hacia la innovación y actualización de los programas porque en la enseñanza de esta disciplina es preciso revisar y adaptar continuamente los conceptos y contenidos, además de la metodología; éstas y otras adaptaciones proponía el profesor Marcelo Alonso ya en el año 1997 en respuesta a la pregunta ¿enseñamos bien la física?, durante el 27º Encuentro Ibérico de Enseñanza de la Física.
No se consigue ni rápido ni fácilmente ser una buena profesora de física.

Fig. 3. Izquierda, Portadas de algunos libros de comunicaciones de los Encuentros Ibéricos de Enseñanza de la Física. Derecha, Portada de una monografía de aprendizaje activo de física básica universitaria
Para lograrlo le citaré a la estudiante algunos de los requisitos que considero significativos y que serán importantes retos para quien desea ser una excelente profesora. En síntesis, estos requisitos son: Saber física. Informarse sobre las innovaciones de la ciencia física. Conocer y relacionar entre sí sus aplicaciones tecnológicas, impactos en la sociedad y consecuencias ambientales. Presentar el impacto de la sociedad en la ciencia y en la enseñanza. Contribuir como educadora al desarrollo sostenible y el mejoramiento del conjunto de la sociedad. Estar al tanto de las experiencias de los profesores que hacen investigación didáctica. Saber enseñar física con el adecuado rigor científico. Contextualizar el nivel de enseñanza y la orientación de los estudios universitarios en que han matriculado los estudiantes.
La profesora de física también deberá saber aplicar las distintas metodologías didácticas para conectar con el estudiante, motivarle en su aprendizaje, fomentar su interés por la ciencia que se estudia y su investigación, reforzar el interés por la cultura científica, hacer uso de las nuevas tecnologías de la información y la comunicación. Difundir sus experiencias innovadoras [5] y sus resultados de investigación didáctica en monografías, revistas y congresos (Fig. 3) estará también entre sus retos... y, por supuesto, gustarle mucho lo que hace y sentir pasión por aprender y enseñar física a sus alumnos.
A modo de cierre
Esas son algunas de las respuestas a las inquietudes de la joven estudiante; espero que le hagan reflexionar y le sirvan para fortalecer su entusiasmo por aprender y enseñar física. Si es así, estoy convencida que dentro de pocos años volverá a visitarme para decirme que está en el camino de…. ¡ser profesora de física!
Referencias:
[1] Tricio Gómez, V. y Valdés Castro, R. (2015) Los científicos y la divulgación de la ciencia. Divulgación. Innovación en la enseñanza de las ciencias. Reflexiones, experiencias y buenas prácticas", pp.83-111, Ed. Q Divulgación. ISBN 13: 978-84-15575-04-7.
[2] Galán, A. y Rubalcaba, L. (2007) El perfil del profesor universitario. Fines, motivación y ámbito del trabajo en la universidad. En A. Galán (ed.), pp. 33-55. Madrid: Encuentro
[3] García Sanz, Mª. Paz y Maquilón Sánchez, J. (2010). El futuro de la formación del profesorado universitario. REIFOP, 14 (1), 17-26. http://www.aufop.com/ (consultada el14-08-17)
[4] Tricio, V. y al. Los Encuentros Ibéricos sobre Enseñanza de la Física (2013). La vida de la Ciencia, REF, 27-1, pp.17-22.
[5] Experiencias de Innovación docente en la enseñanza de la física universitaria. Ed. A. Nájera y E. Arribas. ISBN 978-1-4457-3466-8.
Verónica Tricio Gómez
Doctora en Ciencias Físicas
Profesora Titular de Universidad, Área de Física Aplicada, Departamento de Física, Universidad de Burgos.
No os voy a engañar, la carrera de rastreador de materia oscura no existe, no la busquéis después de hacer la selectividad. En realidad soy físico teórico y estudio la materia oscura, pero de la otra manera suena mucho mejor.
Mentiría si dijese que desde pequeño quería ser físico teórico. De hecho, hasta segundo de Bachiller no sabía que la física iba más allá de los planos inclinados, los movimientos rectilíneos uniformes y acelerados, las fuerzas y poco más. Me habían contado un poco de la gravedad pero solo que era una fuerza que producía una aceleración hacia abajo. Hasta primero de Bachillerato la física no va más allá de la cinemática y la dinámica. Sin embargo, esto no es así. Ni de lejos. Cuando llegas a segundo de Bachiller, posiblemente el año más estresante de la vida de un estudiante, te empiezan a hablar un poco de cosas como campos eléctricos, magnéticos y gravitatorios, de que hay partículas que se desintegran sin venir a cuento o de que el tiempo es relativo. Y despertó una curiosidad que antes no estaba. Por supuesto ese año lo único importante que había que hacer era prepararse para la selectividad y eso fue para todo lo que hubo tiempo. Pero por suerte mi profesor de física de ese año era físico, que puede sonar a obvio pero no lo es para nada, y entre ejercicio y ejercicio intentaba contarnos un poco el trasfondo de esas fórmulas que nos teníamos que aprender. Una vez acabado el estrés del año, hablando con él me dijo que si sentía curiosidad por todo lo que habíamos visto que hiciese la carrera de física para intentar resolver las dudas. Y eso hice.
Una vez en la carrera aprendes que la física es ese maravilloso mundo en el que por cada duda que resuelves te salen 27 nuevas (el número varía pero siempre aparecen dudas nuevas, siempre) y que cuanto más sabes más te queda por saber. Lo que te habían enseñado hasta primero de Bachiller era solo una pequeñísima parte de la mecánica. Y la mecánica era solo una pequeña parte de lo que es la física. Empiezas a aprender de dónde salen las fórmulas y profundizas en todo lo que viste en segundo de Bachillerato. Lo que antes era un tema ahora se convierte en una asignatura anual. Y como ya he dicho, sí, resolver dudas, resuelves. Pero empiezas a ver que el mundo no es tan simple como podías pensar. Te enseñan cosas como la relatividad especial y te empiezan a decir que el mundo depende de quién lo mire, que lo que para uno va a una velocidad o mide una longitud determinada para otro la velocidad y la longitud son distintas por el simple hecho de que el otro se está moviendo. O, incluso, que dos sucesos que para ti pasan en dos momentos diferentes para otra persona pueden pasar a la vez. O la física cuántica que te dice que un gato está vivo y muerto al mismo tiempo hasta que se demuestre lo contrario y que las partículas pueden desintegrarse de repente en otras sin que les hayamos hecho nada. Y aunque todo esto te suena a cuento chino en un primer momento, te lo demuestran con "simples" matemáticas. Ahí fue cuando decidí ser físico teórico. Ves que el mundo funciona de maneras muy "antiintuitivas", pero al mismo tiempo te demuestran que es así. Y quieres saber más.
Una vez terminada la carrera y el máster en Valencia me vine a Madrid a hacer el doctorado, sin tener mucha idea de qué hacer. Y mi director de tesis me habló de algo llamado materia oscura, en la que, en el momento que escribo esto, llevo tres años trabajando.
Probablemente la gran mayoría de vosotros no hayáis oído hablar de la materia oscura. Normal. Todo el mundo que me pregunta de qué va mi doctorado, al escuchar que estudio la materia oscura la segunda pregunta que sueltan suele ser un "¿y eso qué es?". La respuesta es que no lo sé. Después de esto quizás penséis que soy un farsante que os está vendiendo la moto y ni siquiera sabe qué es lo que estudia y puede que hasta cierto punto tengáis razón. Pero lo cierto es que ni lo sé yo ni lo sabe nadie. Qué es la materia oscura es uno de los misterios sin resolver de la astrofísica y la física de partículas.
Todo lo que podemos ver y tocar está formado por un tipo de materia que se llama bariónica. Esta materia está formada por los quarks y leptones y, junto con las cuatro tipos de interacciones fundamentales, podemos intentar entender cómo funciona el universo, tanto desde el punto de vista subatómico (con las interacciones electromagnética, fuerte y débil), como el macroscópico (con la interacción gravitatoria). Desde por qué si hay partículas que se desintegran espontáneamente nosotros seguimos enteros y no vamos disparando partículas a la gente por allá donde vamos, por qué brilla una estrella o por qué se mueven los astros como se mueven, por ejemplo. Y aunque todavía hay detalles importantes de esta materia que estamos intentando averiguar, tenemos un conocimiento bastante considerable de ella.
El problema viene cuando descubres que, de todo el contenido del universo, la materia bariónica solo constituye alrededor del 5% del total. El resto está formado por materia oscura, cerca de un 25% y energía oscura, el 70 restante. Y lo que sabemos de estos dos es más bien poco.
En el caso de la materia oscura, estudiarla es un poco complicado porque no podemos verla. Para ver cualquier cosa se necesita que interaccione con la luz o, dicho de otro modo, que interaccione electromagnéticamente. La materia oscura ni emite ni absorbe luz de ningún tipo. Los fotones, las partículas de luz, simplemente la atraviesan. Por tanto, ningún telescopio de ningún tipo puede ver luz que venga directamente de la materia oscura. Sin embargo sabemos que existir existe. Hemos observado los efectos gravitatorios que produce en el resto de la materia visible. Por ejemplo que la galaxia en la que nos encontramos gira a mayor velocidad de la que debería si solo consideramos la materia que vemos y esto es debido a que también está la materia oscura que no vemos. Con esos efectos gravitatorios los astrofísicos han sabido medir aproximadamente cuánta hay y cómo se distribuye, pero ahí termina todo lo que sabemos sobre ella. No tenemos ni idea de qué tipo de partículas la forman y cómo interacciona, si es que lo hace, con la materia bariónica. Averiguar eso es el trabajo de los físicos teóricos y experimentales que nos dedicamos a estudiarla. Mientras que los experimentales intentan medir las características de la materia oscura, los teóricos nos dedicamos a hacer los modelos que expliquen los resultados que obtienen los experimentales y además predigan nuevas características que les guíen en la manera de buscar indicios de materia oscura. Hasta ahora, por desgracia, no ha habido ninguna medida directa de materia oscura, aunque seguimos buscando.
No obstante la materia oscura no es el único misterio sin revolver de la física. Incluso dentro de la materia bariónica hay muchos fenómenos sin explicación y el trabajo de un físico teórico es encontrarla. Por eso aparte de los rastreadores de materia oscura también hay cazadores de neutrinos, exploradores del vacío y una gran variedad de físicos teóricos que intentan entender por qué las cosas son como son y funcionan como funcionan.
Quizás algunos de vosotros os planteéis estudiar física porque habéis leído o visto cosas de divulgación en libros o en internet y os ha despertado curiosidad, pero al informarte oyes que vivir de la investigación es muy complicado. Bueno, esto es verdad. Llegar a vivir de la investigación es muy muy muy complicado. Somos muchos para muy pocas plazas y la financiación en investigación no es que sea muy prioritaria en la mayoría de países, por decirlo suavemente. Pero, ¿debe ser esto una razón para no estudiar física? No. No solo de la investigación vive el físico. Aparte de aprender física como tal, en la carrera se aprende a pensar y trabajar de un modo que, por ejemplo, no aprende un estudiante de economía. Por eso en empresas y bancos se buscan físicos y matemáticos para puestos relacionados con las finanzas, aprendiendo programación podréis optar a puestos relacionados con desarrollo de software o si os gusta enseñar podéis convertiros en profesores. Y esto solo son unos ejemplos. La realidad es que la carrera de física es una de las carreras con menos índice de paro, a pesar de lo que piensa la gente. Si la investigación no es vuestro camino, con poco esfuerzo podéis orientaros hacia otras áreas de empleo. Por tanto a la hora de elegir si estudiar física o no, dejad a un lado el tema laboral, porque lo normal es que en el momento de elegir carrera no sepáis dónde queréis terminar trabajando.
Si os interesa la física estudiad física, no para trabajar en esto o aquello, sino simplemente para aprender física.
Javier Quilis
Estudiante de Doctorado en Física Teórica
Universidad Autónoma de Madrid, UAM
En Matemáticas, la solución de muchos problemas no consiste en realizar cálculos (álgebra) o medir distancias (geometría), sino en entender la configuración o la estructura de un objeto.

Fig. 1. Los puentes de Königsberg
El primero en resolver una cuestión así fue el matemático suizo Leonhard Euler (1707-1783), al que plantearon el siguiente acertijo (ver Fig. 1): "En la antigua ciudad de Königsberg, en Prusia, el río Pregel forma dos islas que están unidas entre ellas y a las orillas por siete puentes. ¿Es posible hacer un paseo que recorra todos los puentes y pase una sola vez por cada uno?"Como puedes ver, este problema no depende del tamaño de la ciudad, ni de la longitud de los puentes, ni de si están lejos o cerca unos de otros, sino de la manera en que conectan las distintas porciones del terreno. Es un problema "topológico". La gran innovación de Euler fue estudiarlo de manera abstracta, lo que le permitió demostrar que no existe tal paseo, además de dar un método para estudiar cualquier número de puentes y regiones.
¿Qué es la Topología?
La Topología es una rama de las Matemáticas, que tiene muchas aplicaciones en otras disciplinas científicas como la Física, la Ingeniería o la Biología. Es una versión moderna de la geometría, que permite estudiar todo tipo de situaciones desde un punto de vista cualitativo y estructural, más que cuantitativo, y aun así extraer información valiosa. Resuelve problemas que no dependen de la forma exacta de los objetos implicados, sino de la manera en que están colocados, y no importa si los deformamos, retorcemos o estiramos; eso sí, sin romper ni hacer agujeros. La Topología se fija en propiedades que son "invariantes", es decir, que no cambian aunque deformemos los datos, como en el problema de Königsberg, donde a cada región del plano le corresponde el número de puentes que la conectan con las otras regiones. A continuación veremos otros temas que interesan a la Topología.
La característica de Euler-Poincaré
Los "sólidos platónicos" (tetraedro, cubo, octaedro, dodecaedro e icosaedro) son conocidos desde la antigüedad. En el siglo XVIII, Euler se dio cuenta de que todos cumplen la siguiente fórmula: V-A+C=2, donde V es el número de vértices, A es el número de aristas y C es el número de caras.Por ejemplo, en el cubo (ver Fig. 2) tenemos V=8 vértices, A=12 aristas y C=6 caras, de modo que V-A+C vale 2 (se llama su "característica de Euler").
El mismo resultado se obtiene con objetos más complicados, como el "icosaedro truncado" de la Fig. 2, que posee V=60 vértices, A=90 aristas, 12 caras pentagonales y 20 hexagonales; por tanto, C=32, así que su característica también es 2.

Fig. 2. El cubo, el icosaedro truncado y una esfera
Lo que tienen en común todas estas figuras es que son deformaciones de una "esfera" (la superficie de una pelota), como puedes comprobar si piensas en el conocido balón de fútbol de la Fig. 2.

Fig. 3. Una rosquilla “topológica”
En cambio, a diferencia de las anteriores, la característica de un "toro" (la superficie de una rosquilla), vale cero, como puedes comprobar si calculas V, A y C en la Fig. 3. Vemos así que la característica de Euler es un "invariante" topológico que permite distinguir unas superficies de otras.
Se considera al matemático francés Henri Poincaré (1854-1912) como el fundador de la topología moderna. En su época, y debido a la aparición de la teoría de la relatividad y de las llamadas "geometrías no euclidianas", los físicos y los matemáticos empezaron a plantearse el estudio de las posibles "formas" que puede tener el espacio-tiempo en que vivimos, y fue él quien generalizó la característica de Euler a dimensiones superiores.
La banda de Moebius
Existen otros invariantes topológicos que son aún más sutiles. El matemático alemán Augustus Möbius (1790-1868) descubrió la curiosa superficie de la Fig. 4, que se obtiene pegando una banda alargada de papel, pero dando un giro a los extremos antes de unirlos.

Fig. 4. La banda de Möbius y el cilindro
Como puedes comprobar por ti mismo, es imposible colorear una cara y la otra no ¡porque solo tiene una cara! Además, el borde está formado por una única circunferencia (no como el cilindro, que tiene dos bordes). En el vídeo de la referencia [3] el topólogo Raúl Ibáñez explica qué ocurre si cortas una banda de Möbius a lo largo. Tendrás un resultado diferente según que cortes exactamente por el centro (obtendrás una cinta más larga y retorcida) o a un tercio de distancia del borde (en este caso obtendrás ¡dos cintas separadas pero enlazadas!). El invariante que está detrás de estos extraños fenómenos es la "orientabilidad", es decir la posibilidad de decir cuando se está "hacia arriba" y cuando se está "hacia abajo". El cilindro es "orientable", pero la banda de Möbius no.
Teoría de nudos
Una teoría topológica muy interesante es el estudio de los "nudos". En Topología, para simplificar, se supone que los dos extremos del cordel están unidos.

Fig. 5. Tres nudos
Todos los nudos son deformaciones de una circunferencia, pero se trata de decidir si podemos desenredarlos o no, es decir, si hay una transformación de todo el espacio que convierta un nudo en otro. ¿Podrías decidir si hay una manera de transformar los tres nudos de la Fig. 5 entre ellos sin cortarlos?
Un juego topológico
El siguiente juego fue inventado por el matemático inglés John H. Conway (1937- ), y se conoce con distintos nombres (juego de los brotes, juego de las coles de Bruselas). Se empieza dibujando dos puntos (los "brotes") y después por turno cada jugador traza una línea que empiece y acabe en un brote (vale que sea el mismo punto), y dibuja un nuevo brote en el medio de la línea.

Fig. 6. Una partida de “brotes”
Las líneas pueden tener cualquier forma, pero no pueden cortarse. Además, cuando de un brote salen tres líneas, se considera que está muerto y ya no puede usarse. Se pierde el juego cuando ya no se puede dibujar ninguna línea. Es una situación claramente topológica (no importa demasiado la posición de los puntos ni la forma de las curvas) y hay resultados interesantes: por ejemplo, una partida no puede durar menos de cuatro jugadas ni más de cinco. Posibles variantes del juego son: empezar con más puntos, o permitir que de cada brote puedan salir cuatro ramas en vez de tres.
En el blog de mi amigo el mago Moebius (referencia [6]) encontrarás más juegos topológicos.
Algunas aplicaciones de la Topología
La Topología se considera una parte de la "matemática pura" y en principio no está enfocada a problemas que tengan una aplicación directa. De todos modos, en la actualidad ya tiene muchas aplicaciones. Veamos algunas.
-Física. La Topología se usa en la física de la materia condensada, para explicar el comportamiento de superfluídos y superconductores. El premio Nobel de Física de 2016 se otorgó a tres investigadores americanos que usaron la Topología para estudiar cambios de fase diferentes de los usuales (sólido, líquido y gaseoso).
-Robótica. Para planificar el movimiento de uno o más robots es necesario conocer el conjunto de posiciones posibles (el "espacio de configuraciones") e implementar instrucciones ("algoritmos") para que se muevan sin colisiones. Es necesario estudiar un invariante, la llamada "complejidad topológica", para saber cuántos algoritmos se necesitan para cubrir todas las posiciones posibles.
-Biología. En el estudio del cerebro aún no conocemos bien la relación entre la complejidad de las conexiones de una red de neuronas y la función que realizan. La topóloga Katrhyn Hess (1967- )está usando técnicas de "topología algebraica" para esquematizar el flujo de información y entender cómo se procesan los estímulos.
-Química. La Topología juega un papel destacado cuando se estudia la estructura tridimensional de nuevas moléculas con propiedades inusuales o el plegamiento de proteínas.
-Computación. El "análisis topológico de datos" es importante para entender las estructuras complejas que aparecen en muchos procesos mecánicos, físicos y biológicos. Las técnicas topológicas consiguen suficiente información en un tiempo de computación aceptable y proporcionan métodos para describir los datos, como por ejemplo la manera en que están agrupados ("clustering").
-Matemáticas. La Topología se usa en un montón de resultados interesantes: teoremas del punto fijo, existencia de soluciones de ecuaciones, comportamiento cualitativo de modelos matemáticos, teorema de la curva de Jordan, teorema de la esfera peluda, conjetura de Poincaré, …
A modo de conclusión
Cuando miramos el plano del metro de una gran ciudad (Fig. 7) tenemos una información que no es "geométrica" (distancias, ángulos) sino "topológica" (estructura, conexiones, ciclos).

Fig. 7. El metro de Valencia
La Topología estudia "espacios" abstractos, que tanto pueden representar el escenario de un experimento físico como las posibles configuraciones de una máquina o de una molécula de ADN. Desde el punto de vista de la Topología, dos espacios son equivalentes si pueden ser transformados el uno en el otro deformándolos sin cortar ni pegar. Un chiste clásico dice que un topólogo ¡no es capaz de distinguir una rosquilla de una taza con asa!
Referencias:
[1] Los puentes de Königsberg: Matemáticas en el Mundo Moderno, Editorial Blume 1974.
[2] Característica de Euler: https://es.wikipedia.org/wiki/Caracter%C3%ADstica_de_Euler.
[3] Banda de Moebius: http://www.rtve.es/alacarta/videos/orbita-laika/orbita-laika-banda-moebius/2949086/.
[4] Nudos: https://es.wikipedia.org/wiki/Teor%C3%ADa_de_nudos, ver también la versión en inglés.
[5] Juego de los brotes: M. Gardner, Carnaval matemático, Alianza Editorial, 1995.
[6] Juegos topológicos: https://topologia.wordpress.com/.
Copyright de las figuras: Fig. 1: The Euler archive E53; Fig. 2: Eigil Nielsen Select Sports; Fig. 7: Metrovalencia. Wikimedia Commons, the free media repository: Fig. 2: File: Hexahedron.jpg, File: Truncatedicosahedron.jpg., Fig. 3: File: Hexagonal torus.png, Fig. 4: File: MobiusStrip-01.png, File: Cylinder-Ruled-Surface.png, Fig. 5: File: Blue Figure-Eight Knot.png, Fig. 6: File: Sprouts-2spot-game.png
Enrique Macías Virgós
Doctor en Matemáticas
Profesor del área de Geometría y Topología de la Universidad de Santiago de Compostela
"Y ahora, después de todo, viene éste y nos dice que quiere ser como su profe. Lo que nos faltaba."
Estoy convencido de que esta es una manera suave de expresar el pensamiento que estaréis teniendo la mayoría de los que lleguéis hasta aquí en vuestra lectura de este libro. Os quiero confesar que en ningún momento mi idea era participar con un capítulo. No quiero que este apéndice se entienda como tal. Más bien se puede entender como una reflexión en voz alta y con el permiso de todos vosotros un pequeño homenaje.
En el transcurso del año, o casi, que llevo embarcado en este libro siempre me ha movido el mismo pensamiento, intentar divulgar ciencia motivando a chavales a ser científicos. Tengo que confesar que según iba avanzando este proyecto cada vez me gustaba más, no solo como participe en la elaboración sino como lector. Aunque no estoy "exactamente" en el rango de edad al que va dirigido, me paso por una treintena larga, lo he disfrutado y lo disfruto ya más tranquilamente.
Creo que recoge perfectamente la idea inicial de "amigos ayudarme a despertar vocaciones científicas, a despertar esa curiosidad innata que todos los quinceañeros tienen y que van dejando a un lado por otras inquietudes" y, casualidades de la vida, mis hijos se están acercando a esas edades.
En mi posición de lector, me encanta aprender cosas nuevas y en la elaboración y lectura de este libro he aprendido multitud de ellas. Pero sobre todo lo que más me ha gustado de la lectura de todos estos capítulos es descubrir la inmensa cantidad de cosas que todavía tengo por aprender.
Coincido en muchas de las opiniones que se han vertido en este libro y sobre todo con algunas de las que se han repetido bastantes veces: la motivación que suele despertar la lectura de un buen libro de divulgación a edades tempranas, y sobre todo la influencia muy positiva que tiene un buen profesor de Instituto.
Es por ello que quiero aprovechar y rendir un pequeño homenaje a "mí Profe" del Instituto, sin desmerecer con ello al resto de los profesores que tuve. Lo quiero hacer copiando unas líneas que redacté hace cuatro años con motivo del homenaje que le dieron en el Instituto, en un acto donde se descubría una placa en el Laboratorio de Física con su nombre. Este acto iba precedido de varios discursos en el salón de actos y yo me preparé uno por si se daba la circunstancia de que alguno de sus alumnos tuviera que decir unas palabras, cosa que al final no tuve que hacer.
"""Hola amigos.
Agradeceros a todos vuestra presencia en este acto y a las autoridades del Cervantes por llevarlo a cabo.
Yo anduve por estos pasillos y aulas hace ya 30 años y la verdad es que ahora mismo, al igual que entonces, estoy bastante nervioso al hablar ante un público numeroso. Recuerdo vivamente cuando se me ocurría hacer alguna pregunta en las conferencias divulgativas que D. Ricardo organizaba. Para mí en aquellos años los nervios se debían, por un lado, a hablar en público y, por otro, por a la pregunta en sí misma. Siempre tenía la duda sobre si la pregunta sería adecuada, o si el público, el ponente y, sobre todo, D. Ricardo la encontrarían una obviedad o una tontería. Realmente creo que si hay una persona que se merece un homenaje y un acto como el que celebramos hoy, esa persona es D. Ricardo, o si se me permite la licencia, "El Richi", que era como le llamábamos de forma coloquial entre los alumnos en aquellos años. Creo que hablo en nombre de muchos de sus alumnos cuando digo que el haber pasado por sus clases fue un auténtico placer, bueno había que trabajar un poco o bastante. Las clases eran muy amenas, llenas de divertidas anécdotas, sin perder rigurosidad, y para los que queríamos ir un poco más allá de lo que marcaba el temario nos daba la oportunidad de hacerlo. También es de resaltar su labor a la hora de inculcarnos valores fundamentales para chavales de quince años: la importancia de la familia, el compañerismo, el esfuerzo, la honradez, etc.
De los diversos momentos de aquellos años querría resaltar algunos que recuerdo vivamente:
-En segundo (de BUP), el primer día de clase de Física y Química, además de presentarse él y de presentar la asignatura que nos iba a impartir, nos recomendó varias lecturas que nos vendrían bien. Creo que uno de aquellos libros, que aún conservo y que fue uno de los primeros que, por iniciativa propia, me compré y leí con avidez. era el Momentos Estelares de la Ciencia de Isaac Asimov.
-Durante los tres años que tuve la suerte de tenerle de maestro, sí maestro o eso era apara mí, sin querer menospreciar a nadie, los demás eran "profes" y D. Ricardo era "Maestro", resaltar la cantidad de recreos, y alguna que otra tarde, que pasamos con él en el laboratorio. Allí se sucedían los bajo su tutela los experimentos de mecánica, óptica, electricidad y magnetismo, y lo que nos fascinó a todos, los de óptica utilizando un láser. En todos los casos los experimentos, fueran más o menos sencillos, tenían un por qué, eran rigurosos y se nos fue haciendo como propio, como el pan nuestro de cada día, el "método científico".
-En lo relacionado con actividades extraescolares mencionar los ciclos de conferencias organizadas por el Instituto o por otras instituciones pero con la presencia siempre en mayor o menor medida de D. Ricardo. De estas conferencias quiero destacar aquellas organizadas, fomentadas o patrocinadas por alguna empresa eléctrica, creo recordar, y que versaban sobre energía eléctrica en general, desde la generación hasta su uso y aplicaciones. También comentar alguna de, no recuerdo como se llamaba el ponente, creo que era de la Universidad de Comillas y que había estado en la NASA, donde la colección de imágenes que nos enseñaba (en aquellos años las conferencias eran con diapositivas y transparencias) eran espectaculares y para todos nosotros únicas. Quiero recordar que a una conferencia de este señor en el Ateneo de Madrid, D. Ricardo nos llevó o nos invitó a que fuéramos, me impresionó mucho, el ambiente del lugar, la historia. Hoy en día todavía presumo de haber estado una vez en el Ateneo, y como no podía ser de otra manera, en aquella conferencia, en aquel lugar de tradición, realice una pregunta al final, poniéndome de pie, cogiendo un micrófono y con las piernas temblando como me pasaba siempre.
Con el paso de los años he seguido manteniendo un cierto contacto con D. Ricardo. En uno de esos contactos despertó en mí una segunda juventud y me matriculé en la UNED, para intentar seguir con los estudios de Física que había abandonado en 2º, años atrás en la Autónoma. Esta vez, como la anterior, tampoco tuve éxito y tras un año volví a abandonar. En otro de esos esporádicos contactos tuve la oportunidad de conocer al profesor Sánchez Ron, fue con motivo del centenario del "nacimiento del átomo" y unas conferencias que dirigía o promovía, pero en aquella ocasión lo que realmente me movía era pasar unas horas con D. Ricardo, volver los dos juntos a casa, contarle como me iba la vida, que me contara como le iba a él y recibiendo sus consejos, sin desmerecer la conferencia realmente creo que lo verdaderamente importante de aquella tarde fue la charla con mi "maestro".
Vuelvo a reiterar mi agradecimiento al Cervantes por este reconocimiento y homenaje. Cuando pienso en Inglaterra, pienso en Cambridge y en el laboratorio Cavendish, cuando pienso en Copenhague pienso en Bohr, cuando pienso en Suiza pienso en la oficina de patentes y en Einstein y cuando pienso en Embajadores pienso en el Cervantes y en D. Ricardo Fernández y "su laboratorio".
Muchas gracias a todos y…
Muchas gracias D. Ricardo Quintín Garrido
Madrid 30 de Octubre de 2013."""
Espero y confío en que este libro ayude a ese "despertar de la fuerza" científica que todos lleváis dentro. Humildemente con que ayude y guíe a alguno de vosotros me doy por satisfecho y creo que el esfuerzo en la elaboración de este libro habrá merecido la pena.

Confío en leer, en un "futuro no muy lejano", los libros de divulgación científica en que participéis vosotros.
Quintín Garrido Garrido
Contable
Aprendiz de Divulgador Científico y "Generador de Ideas Peregrinas"
F I N










